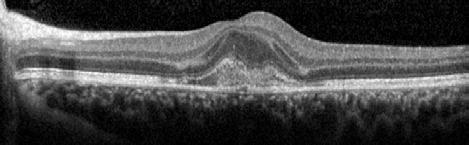
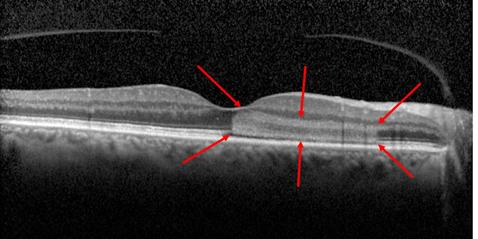
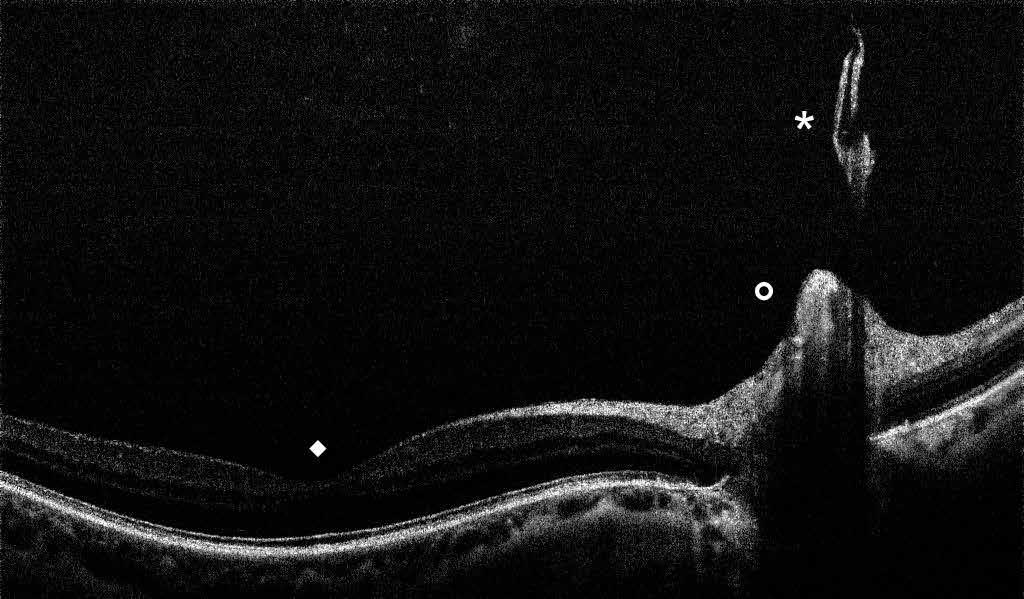
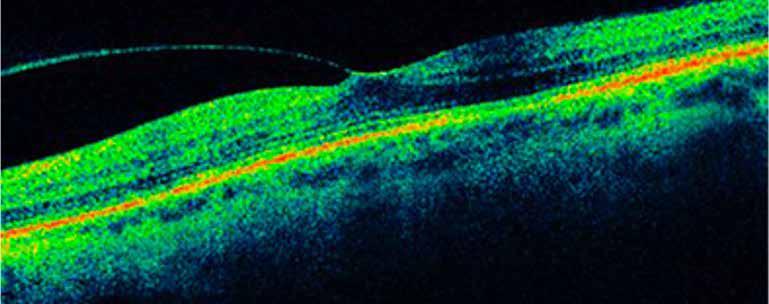
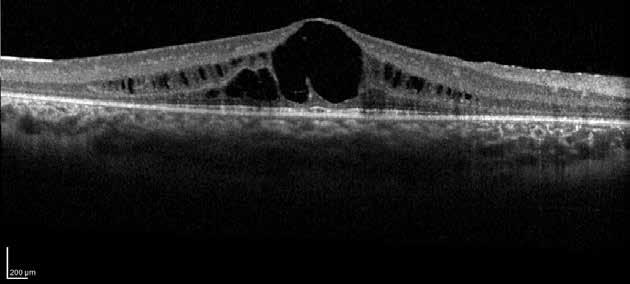
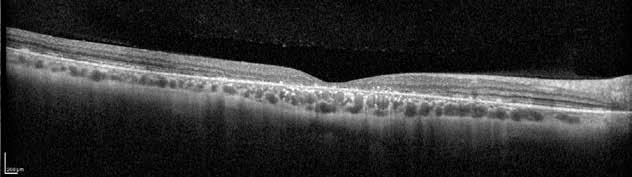

Società Oftalmologi Universitari
President
Leonardo Mastropasqua


Società Oftalmologi Universitari
President
Leonardo Mastropasqua
Board Members
Aragona Pasquale – Bonini Stefano – Boscia Francesco – Donati Simone Fontana Luigi – Gandolfi Stefano – Manni Gianluca – Marchini Giorgio
Mastropasqua Rodolfo – Miglior Stefano – Nardi Marco – Nicolò Massimo
Nubile Mario – Nucci Carlo – Nucci Paolo – Simonelli Francesca
Staurenghi Giovanni – Tognetto Daniele – Vinciguerra Paolo
Chapter Editors
G. Alessio
T. Avitabile
F. Bandello
M.A.Blasi
F. Boscia
P. Carpineto
A. Carta
P. Lanzetta
L. Mastropasqua
R. Mastropasqua
E. Midena
M. Nicolò
P. Nucci
S. Rizzo
F. Simonelli
G. Staurenghi
G. Virgili
Fabiano Gruppo Editoriale
© Copyright 2024
Publisher:
FGE srl - Fabiano Gruppo Editoriale
Editorial office: Strada 4 Milano Fiori, Palazzo Q7 – 20089 Rozzano (MI) – Italy Ph. +39 0141 1706694 – info@fgeditore.it – www.fgeditore.it
Printing: FGE srl - Fabiano Gruppo Editoriale
This publication was made possible thanks to the unconditional contribution of:
The Authors and the Editor decline any responsability for any errors in the text. All rights reserved. Reproduction of this book - total or partial - is strictly forbidden.
ISBN 978-88-31256-70-4
Printed in: December 2024 Sy9_25
It is with great pleasure and honor that I present, on behalf of the Board Members, the first edition of the Ophthalmology Up-To-Date Textbook edited by the University Italian Society of Ophthalmology (SOU). The aspiration of this book is to be a repository of knowledge and provide doctors with an up-to-date, organized and systematic approach to the visual system. This opera is thought to be useful in the daily practice of any ophthalmologist, but also to act as a guide for the general learning of the young ophthalmologists and trainees. The text is supported by a rich iconography with essential bibliography for further insights, and each chapter provides both basic descriptions and more in-detail knowledge in the various topics treated throughout the book. This publication is divided into three compact but complete volumes that will covering the majority of routine ophthalmological practice. In this first volume, dedicated to the dissertation of clinical pathologies, the different sections will be focused on the “Basics in ophthalmology” (from the anatomy of the eye to clinical refraction), “Diseases of the external eye and orbit”, “Pathologies of the anterior segment of the eye” and “Glaucoma and diseases of the uveal tract”. In the following volume the “diseases affecting the posterior segment of the eye”, “pediatric-and neuro-ophthalmology”, “genetic diseases, ocular oncology and correlations between systemic disorders and the eye” will be covered. The last volume of the opera will be dedicated to a complete description of “Instrumental diagnosis, imaging and technology in ophthalmology” and will contain specific and vast sections dedicated to therapeutics including “Laser and surgical procedures in ophthalmology”. It is belief of all the Authors, whom I personally thank for the great effort and work done in producing the chapters of this textbook, that these three volumes can provide an excellent study basis for ophthalmologists in training, (and also for the most experienced doctors) integrating their learning and skills during the clinical work and the surgical experiences, always suggesting to update their knowledge with the essential study of recent research papers and review monographs. I hope that the readers will enjoy and be stimulated by our ophthalmology textbook.
Section 1 Basics in ophthalmology
Section 2 Diseases of the external eye and orbit
Section 3 Diseases of the anterior segment of the eye
Section 4 Glaucoma and diseases of the uveal tract
Section 5 Vitreous and retina
Section 6 Neuro-ophthalmology, pediatrics and injuries
Section 7 Genetic diseases and neoplasia of the eye
Volume 3 Next publishing
Section 8 Instrumental diagnosis, imaging and technology in ophthalmology
Section 9 Ocular therapeutics, lasers and surgery in ophthalmology
Agbeanda Aharrh-Gnama
Ophthalmology Clinic, Department of Medicine and Science of Ageing, University “G. d’Annunzio” Chieti-Pescara, Chieti
Giovanni Alessio
Department of Translational Biomedicine Neuroscience, University of Bari “Aldo Moro”, Bari
Ludovica Alonzo
Department of Neurosciences, Psychology, Drug Research, and Child Health, Eye Clinic, University of Florence, AOU Careggi, Florence
Teresio Avitabile
Department of Ophthalmology, University of Catania
Daniela Bacherini
Department of Neurosciences, Psychology, Drug Research, and Child Health, Eye Clinic, University of Florence, AOU Careggi, Florence
Francesco Bandello
School of Medicine, Vita-Salute San Raffaele University - Department of Ophthalmology, IRCCS San Raffaele Scientific Institute, Milan
Maria Antonietta Blasi
Ophthalmology Department, Catholic University “Sacro Cuore”, Rome
Francesco Boscia
Department of Translational Biomedicine Neuroscience, University of Bari “Aldo Moro”, Bari
Giacomo Boscia
Department of Translational Biomedicine Neuroscience, University of Bari “Aldo Moro”, Bari
Arturo Carta
Ophthalmology Unit, University of Parma
Paolo Carpineto
Ophthalmology Clinic, Department of Medicine and Science of Ageing, University “G. d’Annunzio” Chieti-Pescara, Chieti
Niccolò Castellino
Department of Ophthalmology, University of Catania
Carlo Catti
DiNOGMI, Clinica Oculistica, University of Genoa
Luca Cerino
Ophthalmology Clinic, Department of Medicine and Science of Ageing, University “G. d’Annunzio” Chieti-Pescara, Chieti
Maria Vittoria Cicinelli
School of Medicine, Vita-Salute San Raffaele University - Department of Ophthalmology, IRCCS San Raffaele Scientific Institute, Milan
Lorenzo Cifarelli
Department of Neurosciences, Psychology, Drug Research, and Child Health, Eye Clinic, University of Florence, AOU Careggi, Florence
Federico Corvi
Eye Clinic, Department of Biomedical and Clinical Science “Luigi Sacco”, Sacco Hospital, University of Milan
Ciro Costagliola
Department of Neurosciences, Reproductive Sciences and Dentistry. University of Naples Federico II, Naples
Rossella D’Aloisio
Ophthalmology Clinic, Department of Medicine and Science of Ageing, University “G. d’Annunzio” Chieti-Pescara, Chieti
Francesco Di Bin
Department of Medicine, Ophthalmology, University of Udine
Francesco Dragotto
Department of Neurosciences, Psychology, Drug Research, and Child Health, Eye Clinic, University of Florence, AOU Careggi, Florence
Roberta Farci
Ophthalmology Service, Centre Hospitalier de Perpignan, France
Luisa Frizziero
Department of Ophthalmology, University of Padova
Fabrizio Giansanti
Department of Neurosciences, Psychology, Drug Research, and Child Health, Eye Clinic, University of Florence
Federico Giannuzzi
Ophthalmology Department, Catholic University “Sacro Cuore”, Rome
Matteo Gironi
Ophthalmology Clinic, Department of Medicine and Science of Ageing, University “G. d’Annunzio” Chieti-Pescara, Chieti
Carla Iafigliola
Ophthalmology Clinic, Department of Medicine and Science of Ageing, University “G. d’Annunzio” Chieti-Pescara, Chieti
Paolo Lanzetta
Department of Medicine, Ophthalmology, University of Udine
Rosangela Lattanzio
School of Medicine, Vita-Salute San Raffaele University - Department of Ophthalmology, IRCCS San Raffaele Scientific Institute, Milan
Andrea Lazzerini
Institute of Ophthalmology-University of Modena and Reggio Emilia, Modena
Andrea Lembo
Eye Clinic University “Statale of Milan”, Milan
Arturo Licata
Ophthalmology Clinic, Department of Medicine and Science of Ageing, University “G. d’Annunzio” Chieti-Pescara, Chieti
Celeste Limoli
Eye Clinic University “Statale of Milan”, Milan
Leonardo Mastropasqua
Ophthalmology Clinic, Department of Medicine and Science of Ageing, University “G. d’Annunzio” Chieti-Pescara, Chieti
Rodolfo Mastropasqua
Ophthalmology Clinic, Department of Medicine and Science of Ageing, University “G. d’Annunzio” Chieti-Pescara, Chieti
Edoardo Midena
Department of Ophthalmology, University of Padova – IRCCS Bietti Foundation, Rome
Giulia Midena
IRCCS Bietti Foundation, Rome
Massimo Nicolò
Eye Clinic University of Genoa
Paolo Nucci
Eye Clinic University “Statale of Milan”, Milan
Monica Maria Pagliara
Ophthalmology Department, Catholic University “Sacro Cuore”, Romee
Corrado Pizzo
Department of Ophthalmology, University of Catania
Pasquale Puzo
Department of Translational Biomedicine Neuroscience, University of Bari “Aldo Moro”, Bari
Stanislao Rizzo
Ophthalmology Department, Catholic University “Sacro Cuore”, Rome
Anna Romano
Ophthalmology Clinic, Department of Medicine and Science of Ageing, University “G. d’Annunzio” Chieti-Pescara, Chieti
Leopoldo Rubinato
Department of Medicine - Ophthalmology, University of Udine
Marialudovica Ruggeri
Ophthalmology Clinic, Department of Medicine and Science of Ageing, University “G. d’Annunzio” Chieti-Pescara, Chieti
Maria Grazia Sammarco
Ophthalmology Department, Catholic University “Sacro Cuore”, Rome
Valentina Sarao
Department of Medicine - Ophthalmology, University of Udine
Giancarlo Sborgia
Department of Translational Biomedicine Neuroscience, University of Bari “Aldo Moro”, Bari
Francesco Semeraro
Department of Medical and Surgical Specialties, Radiological Sciences, and Public Health, Ophthalmology Clinic, University of Brescia
Francesca Simonelli
Multidisciplinary Department of Medical, Surgical and Dental Specialities, Università della Campania Luigi Vanvitelli, Naples
Giovanni Staurenghi
Eye Clinic, Department of Biomedical and Clinical Science “Luigi Sacco”, University of Milan
Francesco Testa
Multidisciplinary Department of Medical, Surgical and Dental Specialities, Università della Campania Luigi Vanvitelli, Naples
Beatrice Tombolini
School of Medicine, Vita-Salute San Raffaele University - Department of Ophthalmology, IRCCS San Raffaele Scientific Institute, Milan
Lisa Toto
Ophthalmology Clinic, Department of Medicine and Science of Ageing, University “G. d’Annunzio” Chieti-Pescara, Chieti
Lorenzo Vannozzi
Department of Neurosciences, Psychology, Drug Research, and Child Health, Eye Clinic, University of Florence, AOU Careggi, Florence
Daniele Veritti
Department of Medicine - Ophthalmology, University of Udine
Gianni Virgili
Department of Neurosciences, Psychology, Drug Research, and Child Health, Eye Clinic, University of Florence, AOU Careggi, Florence
2
Section 5 Vitreous and retina
Age-related macular degeneration and other causes of macular neovascularization pag. 13
Retinal vascular disease: diabetic retinopathy pag. 29
Retinal vascular diseases associated with cardiovascular and other systemic diseases pag. 51
Retinal infections and toxicity pag. 75
Choroidal diseases and inflammation pag. 99
Retinal infections pag. 117
Retinopathy of prematurity pag. 139
Posterior vitreous detachment and vitreous hemorrhage pag. 155
Vitreo-macular traction syndrome pag. 169
Rhegmatogenous retinal detachment pag. 181
Proliferative vitreoretinopathy pag. 189
Section 6 Neuro-ophthalmology, pediatrics and injuries
Neuro-ophthalmology pag. 207
Pediatric ophthalmology, refractive errors and amblyopia pag. 249
Ocular injuries pag. 265
Systemic ophthalmology pag. 275
Section 7 Genetic diseases and neoplasia of the eye
Clinical genetics of the eye pag. 289
Anterior segment tumors pag. 301
Posterior segment intraocular tumors pag. 313
Diseases of the retina
Diseases of the Vitreous, vitreo-retinal interface and retinal detachment
Federico Corvi, Giovanni Staurenghi
Macular neovascularization (MNV) is the invasion of abnormal vascular tissue into the retina, particularly the outer retina, the subretinal space, or the sub-retinal pigment epithelium (RPE) space, in various combinations.1 The presence of neovascularization is a pathologic process that could be associated with intraretinal and/or subretinal fluid, hemorrhages and concurrent vision loss. At the same time, MNV can be considered both evidence of an advanced stage of the pathological process as well and a protective ocular response aimed at improving oxygen and nutrient supply to the outer retina and RPE.2
The most common cause of MNV is age-related macular degeneration (AMD), and MNV lesions are classified into three different subtypes based on their anatomical location.
Type 1 MNV is characterized by the growth of vessels from the choriocapillaris into the subRPE space. On fluorescein angiography (FA), Type 1 MNV commonly presents late leakage of undetermined source, defined as areas of leakage at the level of the retinal pigment epithelium in the late phase of the angiogram without well-demarcated areas of hyperfluorescence in the early phase of the angiogram that would explain the leakage. It may also appear as fibrovascular pigment epithelial detachment, defined as areas of irregular retinal pigment epithelium elevation detectable on stereoscopic angiography. As a result, Type 1 MNV was originally termed occult neovascularization.3 Indocyanine green angiography (ICGA) should be used to visualize part of the vascular structure but it often reveals only late staining of the lesion, referred to as a plaque.4 (Figure 1)
Type 2 MNV refers to the proliferation of new vessels originating from the choroid into the subretinal space. These vessels penetrate through the sub-RPE, making the subretinal portion the dominant component of the pathological process in Type 2 neovascularization. On FA, these lesions are usually “well-defined” as they present a well-demarcated area of hyperfluorescence in the early phase of the angiogram, followed by progressive dye pooling in the overlying subsensory retinal space during the late phase. (Figure 2)
Type 3 MNV refers to the growth of vessels from the retinal circulation toward the outer retina. It is believed that vascular proliferation begins in the deep retinal capillary plexus, with the growth vector extending toward the outer retina. On FA and ICGA, Type 3 MNV appears as a hyperfluorescent intraretinal vascular complex with leakage in the late phases of the examination. Late-phase leakage ion ICGA is a unique feature of MNV lesions. Since these lesions originate from the retinal circulation, they never arise within the foveal avascular zone. Instead, they develop near its edge or at a variable distance from it, typically from the terminal portions of third-order arterioles and venules.5 (Figure 3)
Over the years, different hypotheses based on histopathologic data and clinical studies have been proposed to explain the different origins of MNV sub-types in AMD.6–8 In particular, studies have demonstrated choriocapillaris impairment in the context of late AMD, suggesting a key role in the pathogenesis of MNV. Specifically, several histopathologic studies have shown

1. Multimodal imaging of Type 1 macular neovascularization. Fundus autofluorescence (A) showing fine alteration of retinal pigment epithelium. Late phase (B) of fluorescein angiography revealing pinpoints of hyperfluorescence. Both early (C) and late phases (D) of indocyanine green angiography reveal a central hyperfluorescent zone, indicative of type 1 macular neovascularization, consistent with optical coherence tomography angiography (E). Optical coherence tomography displaying a shallow irregular elevation of retinal pigment epithelium (F).
that choriocapillaris density decreases as AMD severity increases.9,10 The advent of OCTA has provided the opportunity to observe the choriocapillaris in-vivo and quantitatively analyze flow deficits. For this reason, choriocapillaris imaging and analysis using OCTA has become one of the hottest topics in recent years.11–15 Several studies have reported a progressive reduction in blood flow in the choroid and choriocapillaris during the progression of AMD. In particular, in neovascular AMD, several studies have observed a dark ring surrounding type 1 MNV. 16,17 It has been hypothesized that this “dark-halo” may result from the mechanical compression of the underlying inner choroid due to the exudative changes leading to inner choroidal ischemia. Alternatively, it may represent a vascular steal phenomenon caused by diverted flow through the neovascular membrane.16,18–21 The choriocapillaris immediately sur-

Figure 2. Multimodal imaging of Type 2 macular neovascularization. Infrared reflectance (A) and fundus autofluorescence (B) revealing abnormalities of retinal pigment epithelium. Early and late phase of indocyanine green angiography (C and D) and fluorescein angiography (E and F) showing a well-defined neovascular network. Optical coherence tomography angiography (G) displaying the neovascular network. Optical coherence tomography (H) showing the neovascularization above the retinal pigment epithelium with disorganization of the overlying inner segment/outer segment junction.
rounding MNV shows greater flow deficits compared to other areas of the macula. This perilesional dark halo in treatment-naïve eyes suggests that RPE hypoxia caused by choriocapillaris disruptions may drive the release of VEGF and the development of MNV.9,17,20,22 As initially hypothesized, patients with MNV may exhibit more localized choriocapillaris impairment, with greater reserve to guide the angiogenesis process, while eyes with atrophic AMD may show more diffuse choriocapillaris lesions, setting the stage for progressive tissue loss as opposed to neovascularization.23,24 Moreover, it has been observed that the choriocapillaris in the peripheral macula differs depending on the MNV subtype, with severe impairment in Type 3 MNV eyes compared to Type 1/2 MNV eyes.25 The widespread choriocapillaris impairment in Type 3 MNV eyes may also explain why these eyes are more prone to developing atrophy compared to Type 1 MNV eyes. However, MNV can also be secondary to other conditions such as high myopia. 26 In pathologic myopia, the progressive posterior segment elongation and deformation may lead to mechanical stress on the retina, causing an imbalance between pro-angiogenic and anti-angiogenic factors, resulting in myopic MNV.27–30 Supporting this, the presence of lacquer cracks has been shown to be a predisposing factor for the development of myopic MNV. 28–30 To

Figure 3. Two examples of Type 3 macular neovascularization. In the first case, Indocyanine green angiography (B) and fluorescein angiography revealing the Type 3 macular neovascularization (arrowhead). Optical coherence tomography (C) showing the detachment of retinal pigment epithelium with the hyperreflective material related to the neovascularization. In the second case, optical coherence tomography (E) showing the intraretinal hyperreflective material related to the neovascularization with intraretinal fluid. Fundus autofluorescence (F) showing abnormalities of retinal pigment epithelium. Optical coherence tomography angiography (G) showing the neovascular lesion.

Figure 4. Multimodal imaging of Type 2 macular neovascularization secondary to pathologic myopia.
Fluorescein angiography (A and B) showing the Type 2 macular neovascularization as an hyperfluorescent area that become more intense with moderate leakage in the late phase. Indocyanine green angiography (C and D) and optical coherence tomography angiography (E) revealing the neovascular network. Optical coherence tomography (F) showing the subretinal hyperreflective material corresponding to the neovascular lesion with subretinal fluid.

Figure 5. Multimodal imaging of Type 1 macular neovascularization secondary to central serous chorioretinopathy. Infrared reflectance (A) and fundus autofluorescence (B) revealing abnormalities of retinal pigment epithelium. Fluorescein angiography (C and D) showing pinpoints of hyperfluorescence. Indocyanine green angiography (E and F) displaying a central hyperfluorescent zone suggesting the increase choroidal hyperpermeability. Optical coherence tomography (G) showing the shallow irregular retinal pigment epithelium elevation with subretinal fluid. Optical coherence tomography angiography (H) revealing the neovascular network.
diagnose myopic MNV, a multimodal imaging approach based on fundus biomicroscopy, FA, ICGA, OCT and OCTA is recommended. Most myopic MNVs present as Type 2 lesions, and the number of anti-VEGF injections required for myopic MNV is generally lower than those required for AMD.31,32 (Figure 4)
MNV may also develop in patients with central serous chorioretinopathy. In this condition, the pathogenesis of MNV is not yet fully understood. It is known that it can occur after laser photocoagulation or photodynamic therapy as a compensatory response to treatment; however, MNV may also develop in cases without history of laser treatment. In these cases, MNV may develop in a manner similar to AMD, where the rupture of Bruch’s membrane due to chronic RPE changes and long-standing serous pigment epithelium detachment allows for the growth of Type 1 neovascularization.33–36 (Figure 6)
It should be noted that MNV may develop in cases without evidence of chronic subretinal fluid, AMD changes, or other degenerative changes. These patients are often diagnosed with neovascularization from an unknown or idiopathic etiology. However, MNV typically grows above focal areas of choroidal thickening and dilated choroidal vessels. The dilation of cho-

Figure 6. Multimodal imaging of Type 1 macular neovascularization secondary to central serous chorioretinopathy. Fluorescein angiography (A and B) showing pinpoints of hyperfluorescence with leakage in the late phase. Indocyanine green angiography (C and D) displaying the central hyperfluorescent area and the adiacent area of choridal hyperpermeability. Fundus autofluorescence (E) revealing abnormalities of retinal pigment epithelium. The en face of optical coherence tomography angiography (F) showing the neovascular network and the B-scan displaying the shallow irregular retinal pigment epithelium elevation with subretinal fluid (G).
roidal vessel can lead to the obliteration of the choriocapillaris and Sattler’s layer, along with concomitant focal RPE alterations, which contribute to the development of MNV.36 The main challenge in these cases is distinguish whether the presence of subretinal fluid is the result of MNV or choroidal hyperpermeability. Imaging techniques can provide valuable insights, but anti-VEGF treatments are the main way to assess the activity status of MNV. Choroidal rupture is a rare but serious complication that occurs in ocular trauma. The rupture typically involves the RPE, Bruch’s membrane, and the choriocapillaris, resulting in visual loss due to macular involvement or the development of MNV.37 The configuration of MNV typically

Figure 7. Multimodal imaging of Type 2 macular neovascularization secondary to choroidal rupture. Blue autofluorescence (A) and infrared reflectance (B) showing the linear change in the retinal pigment epithelium. Optical coherence tomography angiography (C) displaying the choroidal rupture as a regular line of severe choriocapillary rarefaction and a well-defined neovascular network (open arrowheads). Optical coherence tomography (D and E) revealing the rupture of retinal pigment epithelium, Bruch’s membrane and choriocapillaris with subretinal hyperreflective material and subretinal fluid cystoid space.
follows the spatial profile of the choroidal rupture, although in some cases, MNV originates from the rupture and grows laterally without specific correlation to the shape of the Bruch’s membrane break.38 (Figure 7) Similarly, patients with angioid streaks are predisposed to developing MNV. (Figure 8) Angioid streaks appear as irregular, bilateral, narrow, and jagged lines extending from the margin of the optic disc. They result from crack-like breaks in Bruch’s membrane, which is structurally abnormal, making these areas prone to localized ruptures. This process may occur spontaneously or could be secondary to even mild blunt trauma.39 The incidence of MNV ranges from 42% to 86%, and it can manifest bilaterally, often asymmetrically, in up to 71% of cases.40 Higher percentages of MNV have been found in larger and longer lesions, with even higher risk of development when the streaks are located within one disc diameter from the center of the posterior pole.41 MNV in angioid streaks is characterized by frequent recurrence in fact, even after years of inactive disease, new neovascular lesions can arise from a pre-existing lesion or as new area of neovascularization distant from the original lesion.39
Type 2 macular telangiectasia is a bilateral condition of unknown cause, characterized by alterations in the macular capillary network and neurosensory atrophy.42 This condition is as-

Figure 8. Multimodal imaging of Type 2 macular neovascularization secondary to angioid streaks. Infrared reflectance (A) and blue autofluorescence (B) revealing the fundus alterations secondary to angioid streaks. Indocyanine green angiography (C and D) and fluorescein angiography (E and F) showing an hyperfluorescent area that become more intense in the late phase as Type 2 neovascularization. Optical coherence tomography angiography showing the macular neovascularization with a define network that closely followed the trajectory of angioid streak (G). Optical coherence tomography displaying the area of atrophy retinal pigment epithelium changes with the neovascular tissue above the retinal pigment epithelium (H).
sociated with various retinal changes, such as blunting or lack of foveolar reflex, reduced retinal transparency, crystalline deposits, mild capillary ectasia, slightly dilated venules, foveal atrophy, lamellar or full-thickness macular holes and neovascular complexes.42-44 Neovascular lesions appear to be different from MNV in AMD. They seem to originate from the retinal vasculature, but can access the subretinal space and may develop a retinal-choroidal anastomosis. Sometimes, the membranes resemble markedly ectatic capillaries, which could represent a retinal-retinal anastomosis.43,45,46 The development of a neovascular lesion may occur at an advanced stage of the pathological process and lead to frequent vision loss. Neovascular lesions are associated with macular edema, subretinal hemorrhages before progressing to a cicatricial and fibrotic stage. (Figure 9 and 10). Therefore, intervention may potentially be beneficial in the early stages of the disease.46
Macular neovascularization may also occur in the context of intraocular tumors such as choroidal nevi and choroidal osteoma. The choroidal nevus is the most common intraocular tu-

Figure 9. Multimodal imaging of bilateral macular neovascularization and idiopathic macular telangiectasia. MultiColor image (A) revealing the hemorrhage at the posterior pole and the dilated telangiectatic perifoveal vessels. Blue and green fundus autofluorescence (B and C) showing the retinal pigment epithelium changes. Indocyanine green angiography (D and E) and fluorescein angiography (F and G) displaying the macular neovascularization with leakage in the late phase. OCT (H and I) showing the outer retinal atrophy, the subretinal hyperreflective material and the internal changes related to the Müller cell degeneration. MultiColor image (L) revealing the dilated telangiectatic perifoveal vessels and the multiple golden crystalline refractile deposits. Blue and green fundus autofluorescence (M and N) showing the retinal pigment epithelium changes with the loss of macular pigment. Fluorescein angiography (O and P) and indocyanine green angiography (Q and R) displaying the macular neovascularization. OCT (S and T) revealing the outer retinal atrophy, the subretinal hyperreflective material and the full thickness macular hole due to the Müller cell degeneration.

Figure 10. Multimodal imaging of macular neovascularization and idiopathic macular telangiectasia. Blue fundus autofluorescence (A and C) showing the retinal pigment epithelium changes with the loss of macular pigment and the dilated telangiectatic perifoveal vessels. OCT (B) showing a preserved foveal contour without changes in the retinal layers. OCT (D) revealing a large retinal pigment epithelium detachment with a lobular appearance. Fluorescein angiography (E and F) and indocyanine green angiography (G and H) displaying the polypoidal macular neovascularization.

Figure 11. Multimodal imaging of choroidal nevi complicated by neovascularization. Fundus photography (A) revealing the peripapillary choroidal nevus. Indocyanine green angiography (B) and optical coherence tomography angiography (C) showing the polypoidal neovascularization. Fundus photography (D) revealing the choroidal nevus along the superior temporal vascular arcade. Optical coherence tomography (E) displaying flow signal within the sub-retinal pigment epithelium detachment. Optical coherence tomography angiography showing the Type 1 neovascularization (F).
mor and can be identified in approximately 6.5% of eyes as a flat or slightly elevated, well-defined mass, ranging in color from brown to gray, located deep within the retina.47,48 These lesions are benign in nature, with a low potential for visual loss or growth into melanoma.48,49
Predictive factors for central visual loss over time include the primary location of the lesion and secondary changes in overlying retina and RPE, including foveal edema, subretinal fluid, RPE detachment, orange pigment and MNV formation.50-52 Recognizing the characteristics of MNV associated with a choroidal nevus is important, as it can easily be misinterpreted as a sign of malignant transformation into melanoma. The diagnosis of MNV related to the nevus

Figure 12. Multimodal imaging of choroidal osteoma complicated by neovascularization. Infrared reflectance (A and B) showing the peripapillary lesions and indocyanine green angiography (C and D) revealing the hypofluorescent area of bilateral choroidal osteoma. In the left eye, blue fundus autofluorescence (E) showing a temporal hypoautofluorescent area related to and optical coherence tomography angiography (C) showing the polypoidal neovascularization. Fundus photography (D) revealing the choroidal nevus along the superior temporal vascular arcade. Optical coherence tomography (E) displaying flow signal within the sub-retinal pigment epithelium detachment. Optical coherence tomography angiography showing the Type 1 neovascularization (F).
is typically performed with multimodal imaging, including OCT, ICGA, FA and OCTA, to assess the location and size of the MNV in relation to the nevus and the fovea, and plan the appropriate treatment.52 (Figure 11) MNV may occur also in the context of choroidal osteoma.53 Choroidal osteoma is a rare, benign ossifying tumor of the choroid of unknown etiology. MNV is a significant cause of vision loss in patients with choroidal osteoma, and it has been reported to develop in 31% of affected eyes within 10 years.54,55 The mechanism though which MNV develops is primarily considered to be the disruption of the RPE with thinning of Bruch’s membrane and the choriocapillaris, that allows for the concurrent growth of underlying new choroidal vessels, or the osteoma itself may have extensions of the neovascular membrane.56,57 (Figure 12) Various treatments for MNV associated with choroidal osteoma have been explored, including laser photocoagulation, photodynamic therapy, transpupillary thermotherapy, surgical excision and anti-VEGF therapy..58-60 For extrafoveal tumors, serial intravitreal anti-VEGF therapy should be administered

Figure 13. Multimodal imaging of macular neovascularization and punctate inner choroidopathy.
Fluorescein angiography (A and B) and indocyanine green angiography (C) showing the macular neovascularization with leakage in the late phase (B). Fundus autofluorescence (D) displaying the atrophic changes of the outer retina and retinal pigment epithelium. OCT showing the subretinal hyperreflective material related to the macular neovascularization and the spot subretinal hyperreflective material with the cone of hypertransmission.
monthly until control is achieved, followed by consolidation with photodynamic therapy. For subfoveal disease, monthly intravitreal anti-VEGF injections are recommended until control is established, with a treat-and-extend approach to minimize treatment burden. Photodynamic therapy should generally be avoided in cases of subfoveal MNV, as photoreceptor loss due to decalcification may result in limited visual acuity. Most patients with choroidal osteoma can be managed with observation the treatment criteria outlined above apply only in cases of active MNV.60
MNV may develop as a complication of chorioretinal inflammation. In this context, MNV may be the first presenting sign of posterior uveitis or may develop in patients with a prior diagnosis.61 MNV can occur in a wide range of uveitis cases, including both infectious and non-infectious etiologies. Distinguishing inflammatory MNV from other forms may be useful due to the implications for managing both the condition and the associated uveitis. The proposed mechanism for the development of inflammatory MNV involves focal disruption of the RPE caused by infection or inflammation, which leads to growth and invasion of new vessels into the outer retinal space.62,63 The most common cause of inflammatory MNV is punctate inner choroidopathy. Other conditions that may be complicated by the development of MNV include multifocal choroiditis, serpiginous choroiditis, presumed ocular histoplasmosis syndrome, toxoplasma retinochoroiditis, and Vogt-Koyanagi-Harada disease.64 In this context, a detailed patient anamnesis and multimodal imaging analysis, including the recently introduced OCTA technology, are highly valuable for diagnosing and managing inflammatory MNV. Central vision loss due to MNV compromises patients’ ability to engage in certain types of work and daily activities. Considering that uveitis often affects individuals of working age, inflammatory MNV frequently impacts patients during their most productive and active years.64 Patients with inflammatory MNV exhibit some differences compared to other conditions such as AMD. In AMD, MNV can present as Type 1, Type 2 or Type 3 lesions, while the inflammatory MNV typically manifests as Type 2 lesions.65,66 In AMD, MNV is usually subfoveal and associated with the presence of drusen, pigmentary changes, and RPE abnormalities, while in inflammatory MNV, the RPE is often intact. Moreover, inflammatory MNV lesions are highly focal and may respond to fewer injections compared to AMD patients, who often require ongoing VEGF suppression with multiple injections.67 In patients with inflammatory MNV, inflammation drives lesion development, and with adequate inflammation control, the neovascular drive may subside. Management of the underlying uveitis typically involves systemic steroids or steroid-sparing immunosuppressive therapy, combined with the MNV management requiring anti-vascular growth factor agents, with or without concurrent anti-inflammatory and/or corticosteroid therapy.
References
1. Spaide RF, Jaffe GJ, Sarraf D, et al. Consensus Nomenclature for Reporting Neovascular Age-Related Macular Degeneration Data: Consensus on Neovascular Age-Related Macular Degeneration Nomenclature Study Group. Ophthalmology. 2020;127(5):616-636. doi:10.1016/j.ophtha.2019.11.004
2. Grossniklaus HE, Green WR. Choroidal neovascularization. Am J Ophthalmol. 2004;137(3):496-503. doi:10.1016/j.ajo.2003.09.042
3. JD G. Stereoscopic Atlas of Macular Diseases. 4th ed. St.; 1997.
4. Yannuzzi LA, Slakter JS, Sorenson JA, Guyer DR, Orlock DA. Digital indocyanine green videoangiography and choroidal neovascularization. Retina. 1992;12(3):191-223.
5. Freund KB, Zweifel SA, Engelbert M. Edirorial: Do we need a new classification for choroidal neovascularization in age-related macular degeneration? Retina. 2010;30(9):1333-1349. doi:10.1097/IAE.0b013e3181e7976b
6. Yannuzzi LA, Negrão S, Iida T, et al. Retinal angiomatous proliferation in age-related macular degeneration. 2001. Retina. 2012;32 Suppl 1:416-434.
7. Chen L, Li M, Messinger JD, Ferrara D, Curcio CA, Freund KB. Recognizing Atrophy and Mixed-Type Neovascularization in Age-Related Macular Degeneration Via Clinicopathologic Correlation. Transl Vis Sci Technol. 2020;9(8):8. doi:10.1167/tvst.9.8.8
8. Curcio CA, Balaratnasingam C, Messinger JD, Yannuzzi LA, Freund KB. Correlation of Type 1 Neovascularization Associated With Acquired Vitelliform Lesion in the Setting of Age-Related Macular Degeneration. Am J Ophthalmol. 2015;160(5):10241033.e3. doi:10.1016/j.ajo.2015.08.001
9. Bhutto I, Lutty G. Understanding age-related macular degeneration (AMD): relationships between the photoreceptor/retinal pigment epithelium/Bruch’s membrane/choriocapillaris complex. Mol Aspects Med. 2012;33(4):295-317. doi:10.1016/j. mam.2012.04.005
10. Biesemeier A, Taubitz T, Julien S, Yoeruek E, Schraermeyer U. Choriocapillaris breakdown precedes retinal degeneration in age-related macular degeneration. Neurobiol Aging. 2014;35(11):2562-2573. doi:10.1016/j.neurobiolaging.2014.05.003
11. Scharf J, Corradetti G, Corvi F, Sadda S, Sarraf D. Optical Coherence Tomography Angiography of the Choriocapillaris in Age-Related Macular Degeneration. J Clin Med. 2021;10(4). doi:10.3390/jcm10040751
12. Corvi F, Su L, Sadda SR. Evaluation of the inner choroid using OCT angiography. Eye (Lond). 2021;35(1):110-120. doi:10.1038/ s41433-020-01217-y
13. Chu Z, Zhang Q, Gregori G, Rosenfeld PJ, Wang RK. Guidelines for imaging the choriocapillaris using OCT angiography. Am J Ophthalmol. Published online September 2020. doi:10.1016/j.ajo.2020.08.045
14. Corvi F, Tiosano L, Corradetti G, et al. CHORIOCAPILLARIS FLOW DEFICITS AS A RISK FACTOR FOR PROGRESSION OF AGE-RELATED MACULAR DEGENERATION. Retina. 2021;41(4):686-693. doi:10.1097/IAE.0000000000002990
15. Corvi F, Corradetti G, Sadda SR. Correlation between the Angiographic Choriocapillaris and the Structural Inner Choroid. Curr Eye Res. 2021;46(6):871-877. doi:10.1080/02713683.2020.1846756
16. Inoue M, Jung JJ, Balaratnasingam C, et al. A Comparison Between Optical Coherence Tomography Angiography and Fluorescein Angiography for the Imaging of Type 1 Neovascularization. Invest Ophthalmol Vis Sci. 2016;57(9):OCT314-23. doi:10.1167/ iovs.15-18900
17. Jia Y, Bailey ST, Wilson DJ, et al. Quantitative optical coherence tomography angiography of choroidal neovascularization in age-related macular degeneration. Ophthalmology. 2014;121(7):1435-1444. doi:10.1016/j.ophtha.2014.01.034
18. Forster JC, Harriss-Phillips WM, Douglass MJ, Bezak E. A review of the development of tumor vasculature and its effects on the tumor microenvironment. Hypoxia (Auckland, NZ). 2017;5:21-32. doi:10.2147/HP.S133231
19. Rispoli M, Savastano MC, Lumbroso B. Quantitative Vascular Density Changes in Choriocapillaris Around CNV After Anti-VEGF Treatment: Dark Halo. Ophthalmic Surg Lasers Imaging Retina. 2018;49(12):918-924. doi:10.3928/23258160-2018120302
20. Scharf JM, Corradetti G, Alagorie AR, et al. Choriocapillaris Flow Deficits and Treatment-Naïve Macular Neovascularization Secondary to Age-Related Macular Degeneration. Invest Ophthalmol Vis Sci. 2020;61(11):11. doi:10.1167/iovs.61.11.11
21. Alagorie AR, Verma A, Nassisi M, et al. QUANTITATIVE ASSESSMENT OF CHORIOCAPILLARIS FLOW DEFICITS SURROUNDING CHOROIDAL NEOVASCULAR MEMBRANES. Retina. Published online July 2020. doi:10.1097/IAE.0000000000002878
22. Moult E, Choi W, Waheed NK, et al. Ultrahigh-speed swept-source OCT angiography in exudative AMD. Ophthalmic Surg Lasers Imaging Retina. 2014;45(6):496-505. doi:10.3928/23258160-20141118-03
23. Alagorie AR, Verma A, Nassisi M, Sadda SR. Quantitative Assessment of Choriocapillaris Flow Deficits in Eyes with Advanced Age-Related Macular Degeneration Versus Healthy Eyes. Am J Ophthalmol. 2019;205:132-139. doi:10.1016/j.ajo.2019.04.037
24. Corvi F, Corradetti G, Tiosano L, McLaughlin JA, Lee TK, Sadda SR. Topography of choriocapillaris flow deficit predicts development of neovascularization or atrophy in age-related macular degeneration. Graefe’s Arch Clin Exp Ophthalmol = Albr von Graefes Arch fur Klin und Exp Ophthalmol. Published online April 2021. doi:10.1007/s00417-021-05167-3
25. Corvi F, Cozzi M, Corradetti G, Staurenghi G, Sarraf D, Sadda SR. Quantitative assessment of choriocapillaris flow deficits in eyes with macular neovascularization. Graefe’s Arch Clin Exp Ophthalmol = Albr von Graefes Arch fur Klin und Exp Ophthalmol. Published online January 2021. doi:10.1007/s00417-020-05056-1
26. Ferris FL 3rd, Fine SL, Hyman L. Age-related macular degeneration and blindness due to neovascular maculopathy. Arch Ophthalmol (Chicago, Ill 1960). 1984;102(11):1640-1642. doi:10.1001/archopht.1984.01040031330019
27. Seko Y, Seko Y, Fujikura H, Pang J, Tokoro T, Shimokawa H. Induction of vascular endothelial growth factor after application of mechanical stress to retinal pigment epithelium of the rat in vitro. Invest Ophthalmol Vis Sci. 1999;40(13):3287-3291.
28. Ohno-Matsui K, Shimada N, Yasuzumi K, et al. Long-term development of significant visual field defects in highly myopic eyes. Am J Ophthalmol. 2011;152(2):256-265.e1. doi:10.1016/j.ajo.2011.01.052
29. Ohno-Matsui K, Ito M, Tokoro T. Subretinal bleeding without choroidal neovascularization in pathologic myopia. A sign of new lacquer crack formation. Retina. 1996;16(3):196-202. doi:10.1097/00006982-199616030-00003
30. Querques G, Corvi F, Balaratnasingam C, et al. Lacquer Cracks and Perforating Scleral Vessels in Pathologic Myopia: A Possible Causal Relationship. Am J Ophthalmol. 2015;160(4). doi:10.1016/j.ajo.2015.07.017
31. Photodynamic therapy of subfoveal choroidal neovascularization in pathologic myopia with verteporfin. 1-year results of a randomized clinical trial--VIP report no. 1. Ophthalmology. 2001;108(5):841-852. doi:10.1016/s0161-6420(01)00544-9
32. Wolf S, Balciuniene VJ, Laganovska G, et al. RADIANCE: a randomized controlled study of ranibizumab in patients with choroidal neovascularization secondary to pathologic myopia. Ophthalmology. 2014;121(3):682-92.e2. doi:10.1016/j.ophtha.2013.10.023
33. Ergun E, Tittl M, Stur M. Photodynamic therapy with verteporfin in subfoveal choroidal neovascularization secondary to
Age-related macular degeneration and other causes of macular neovascularization
central serous chorioretinopathy. Arch Ophthalmol (Chicago, Ill 1960). 2004;122(1):37-41. doi:10.1001/archopht.122.1.37
34. Cakir M, Cekiç O, Yilmaz OF. Photodynamic therapy for iatrogenic CNV due to laser photocoagulation in central serous chorioretinopathy. Ophthalmic surgery, lasers imaging Off J Int Soc Imaging Eye. 2009;40(4):405-408. doi:10.3928/1542887720096030-10
35. Zayit-Soudry S, Moroz I, Loewenstein A. Retinal Pigment Epithelial Detachment. Surv Ophthalmol. 2007;52(3):227-243. doi:10.1016/j.survophthal.2007.02.008
36. Pang CE, Freund KB. Pachychoroid neovasculopathy. Retina. 2015;35(1):1-9. doi:10.1097/IAE.0000000000000331
37. Ament CS, Zacks DN, Lane AM, et al. Predictors of visual outcome and choroidal neovascular membrane formation after traumatic choroidal rupture. Arch Ophthalmol (Chicago, Ill 1960). 2006;124(7):957-966. doi:10.1001/archopht.124.7.957
38. Preziosa C, Corvi F, Pellegrini M, Bochicchio S, Rosar AP, Staurenghi G. OPTICAL COHERENCE TOMOGRAPHY ANGIOGRAPHY FINDINGS IN A CASE OF CHOROIDAL NEOVASCULARIZATION SECONDARY TO TRAUMATIC CHOROIDAL RUPTURE. Retin cases & Br reports. 2020;14(4). doi:10.1097/ICB.0000000000000704
39. Chatziralli I, Saitakis G, Dimitriou E, et al. ANGIOID STREAKS: A Comprehensive Review From Pathophysiology to Treatment. Retina. 2019;39(1):1-11. doi:10.1097/IAE.0000000000002327
40. Shah M, Amoaku WMK. Intravitreal ranibizumab for the treatment of choroidal neovascularisation secondary to angioid streaks. Eye (Lond). 2012;26(9):1194-1198. doi:10.1038/eye.2012.116
41. Mansour AM, Ansari NH, Shields JA, Annesley WHJ, Cronin CM, Stock EL. Evolution of angioid streaks. Ophthalmol J Int d’ophtalmologie Int J Ophthalmol Zeitschrift fur Augenheilkd. 1993;207(2):57-61. doi:10.1159/000310407
42. Charbel Issa P, Gillies MC, Chew EY, et al. Macular telangiectasia type 2. Prog Retin Eye Res. 2013;34:49-77. doi:10.1016/j.preteyeres.2012.11.002
43. Gass JD, Blodi BA. Idiopathic juxtafoveolar retinal telangiectasis. Update of classification and follow-up study. Ophthalmology. 1993;100(10):1536-1546.
44. Charbel Issa P, Scholl HPN, Gaudric A, et al. Macular full-thickness and lamellar holes in association with type 2 idiopathic macular telangiectasia. Eye (Lond). 2009;23(2):435-441. doi:10.1038/sj.eye.6703003
45. Davidorf FH, Pressman MD, Chambers RB. Juxtafoveal telangiectasis-a name change? Retina. 2004;24(3):474-478. doi:10.1097/00006982-200406000-00028
46. Engelbrecht NE, Aaberg TMJ, Sung J, Lewis M Lou. Neovascular membranes associated with idiopathic juxtafoveolar telangiectasis. Arch Ophthalmol (Chicago, Ill 1960). 2002;120(3):320-324. doi:10.1001/archopht.120.3.320
47. Sumich P, Mitchell P, Wang JJ. Choroidal nevi in a white population: the Blue Mountains Eye Study. Arch Ophthalmol (Chicago, Ill 1960). 1998;116(5):645-650. doi:10.1001/archopht.116.5.645
48. Shields CL, Furuta M, Mashayekhi A, et al. Clinical spectrum of choroidal nevi based on age at presentation in 3422 consecutive eyes. Ophthalmology. 2008;115(3):546-552.e2. doi:10.1016/j.ophtha.2007.07.009
49. Qiu M, Shields CL. Choroidal Nevus in the United States Adult Population: Racial Disparities and Associated Factors in the National Health and Nutrition Examination Survey. Ophthalmology. 2015;122(10):2071-2083. doi:10.1016/j.ophtha.2015.06.008
50. Shields CL, Furuta M, Mashayekhi A, et al. Visual acuity in 3422 consecutive eyes with choroidal nevus. Arch Ophthalmol (Chicago, Ill 1960). 2007;125(11):1501-1507. doi:10.1001/archopht.125.11.1501
51. Waltman DD, Gitter KA, Yannuzzi L, Schatz H. Choroidal neovascularization associated with choroidal nevi. Am J Ophthalmol. 1978;85(5 Pt 1):704-710. doi:10.1016/s0002-9394(14)77109-0
52. Pellegrini M, Corvi F, Say EAT, Shields CL, Staurenghi G. OPTICAL COHERENCE TOMOGRAPHY ANGIOGRAPHY FEATURES OF CHOROIDAL NEOVASCULARIZATION ASSOCIATED WITH CHOROIDAL NEVUS. Retina. 2018;38(7):1338-1346. doi:10.1097/ IAE.0000000000001730
53. Kadrmas EF, Weiter JJ. Choroidal osteoma. Int Ophthalmol Clin. 1997;37(4):171-182. doi:10.1097/00004397-199703740-00015
54. Alameddine RM, Mansour AM, Kahtani E. Review of choroidal osteomas. Middle East Afr J Ophthalmol. 2014;21(3):244-250. doi:10.4103/0974-9233.134686
55. Shields CL, Sun H, Demirci H, Shields JA. Factors predictive of tumor growth, tumor decalcification, choroidal neovascularization, and visual outcome in 74 eyes with choroidal osteoma. Arch Ophthalmol (Chicago, Ill 1960). 2005;123(12):1658-1666. doi:10.1001/archopht.123.12.1658
56. Shields CL, Shields JA, Augsburger JJ. Choroidal osteoma. Surv Ophthalmol. 1988;33(1):17-27. doi:10.1016/0039-6257(88)90069-0
57. Foster BS, Fernandez-Suntay JP, Dryja TP, Jakobiec FA, D’Amico DJ. Clinicopathologic reports, case reports, and small case series: surgical removal and histopathologic findings of a subfoveal neovascular membrane associated with choroidal osteoma. Arch Ophthalmol (Chicago, Ill 1960). 2003;121(2):273-276. doi:10.1001/archopht.121.2.273
58. Blaise P, Duchateau E, Comhaire Y, Rakic J-M. Improvement of visual acuity after photodynamic therapy for choroidal neovascularization in choroidal osteoma. Acta Ophthalmol Scand. 2005;83(4):515-516. doi:10.1111/j.1600-0420.2005.00479.x
59. Shukla D, Tanawade RG, Ramasamy K. Transpupillary thermotherapy for subfoveal choroidal neovascular membrane in choroidal osteoma. Eye (Lond). 2006;20(7):845-847. doi:10.1038/sj.eye.6702016
60. Khan MA, DeCroos FC, Storey PP, Shields JA, Garg SJ, Shields CL. Outcomes of anti-vascular endothelial growth factor therapy in the management of choroidal neovascularization associated with choroidal osteoma. Retina. 2014;34(9):1750-1756. doi:10.1097/IAE.0000000000000187
61. Agarwal A, Invernizzi A, Singh RB, et al. An update on inflammatory choroidal neovascularization: epidemiology, multimodal imaging, and management. J Ophthalmic Inflamm Infect. 2018;8(1):13. doi:10.1186/s12348-018-0155-6
62. Gass JD. Pathogenesis of tears of the retinal pigment epithelium. Br J Ophthalmol. 1984;68(8):513-519. doi:10.1136/bjo.68.8.513
63. Grossniklaus HE, Gass JD. Clinicopathologic correlations of surgically excised type 1 and type 2 submacular choroidal neovascular membranes. Am J Ophthalmol. 1998;126(1):59-69. doi:10.1016/s0002-9394(98)00145-7
64. Baxter SL, Pistilli M, Pujari SS, et al. Risk of choroidal neovascularization among the uveitides. Am J Ophthalmol. 2013;156(3):468-477.e2. doi:10.1016/j.ajo.2013.04.040
65. Told R, Sacu S, Hecht A, et al. Comparison of SD-Optical Coherence Tomography Angiography and Indocyanine Green Angiography in Type 1 and 2 Neovascular Age-related Macular Degeneration. Invest Ophthalmol Vis Sci. 2018;59(6):2393-2400. doi:10.1167/iovs.17-22902
66. Corvi F, Cozzi M, Barbolini E, et al. COMPARISON BETWEEN SEVERAL OPTICAL COHERENCE TOMOGRAPHY ANGIOGRAPHY DEVICES AND INDOCYANINE GREEN ANGIOGRAPHY OF CHOROIDAL NEOVASCULARIZATION. Retina. 2020;40(5):873-880. doi:10.1097/ IAE.0000000000002471
67. Ba J, Peng R-S, Xu D, et al. Intravitreal anti-VEGF injections for treating wet age-related macular degeneration: a systematic review and meta-analysis. Drug Des Devel Ther. 2015;9:5397-5405. doi:10.2147/DDDT.S86269
Beatrice Tombolini, Maria Vittoria Cicinelli, Rosangela Lattanzio, Francesco Bandello
Introduction
Diabetic retinopathy (DR) is the most common ocular manifestation of diabetes and the leading cause of blindness among the working-age population in industrialized countries. (1) Clinically, DR is classified as non-proliferative (NPDR) and proliferative diabetic retinopathy (PDR), based on the development of anomalous new blood vessels on the retina, optic disc, or iris. Late-stage complications are vitreous hemorrhages, tractional retinal detachment, and neovascular glaucoma. However, the most prevalent cause of vision loss is diabetic macular edema (DME), which may affect all stages of the disease. (2)
Early identification of DR is crucial since symptoms become noticeable only in severe cases. Nowadays, screening procedures employ modern technologies (multimodal imaging, telemedicine, artificial intelligence) to prevent DR-related blindness. (3)
So far, therapeutic management has dramatically changed, shifting from laser photocoagulation being the benchmark treatment to the latest formulations of antiangiogenic intravitreal and slow-release corticosteroid implants. (4)
This chapter provides a comprehensive and up-to-date overview of the epidemiological and clinical characterization of diabetic retinopathy, focusing on its diagnostic, screening, and therapeutic management.
The prevalence of diabetes is steadily and undoubtedly rising worldwide. It is estimated that by 2045 diabetes will affect 783 million people aged 20 to 79, representing 12.2% of the global adult population.(5) Similarly, its global prevalence and disease burden are expected to increase significantly, reaching 130 million by 2030, and further rising to 161 million by 2045. This trend is attributed to several factors, including growing global prevalence of diabetes, lifestyle changes, and aging of the global population. Concurrently, a geographic shift is becoming evident. Projections by 2030 suggest that DR prevalence will grow at comparatively modest rates (10.8-18.0%) in traditionally affluent areas (North America and Europe), while in middle- and low-income regions (Western Pacific, South and Central America, Asia, Africa, Middle East and North Africa), these rates will be substantially higher (20.6-47.2%). The most recent meta-analysis (2020-2021) estimated a global prevalence of DR at 103 million (22.3% of DM population). (6) In Europe, the prevalence of DR was slightly below global values (18.8%). In 2016, the number of Italian diabetic patients reached 3.5 million (5.5% of total population), with one-third aged 65 and above. So far, there is no national data on the prevalence and incidence of legal blindness in patients with diabetes or DR, although available data are consistent with European reports. (7)
The incidence of diabetic retinopathy may vary based on insulin dependence, with a higher frequency in type 1 rather than type 2 diabetes (39-59% vs 3.8-38.6%, respectively). (8) The most
Diabetes Control and Complications Trial
DCCT
Follow-up study to the DCCT titled Epidemiology of Diabetes Interventions and Complications EDIC
Diabetic Retinopathy Study
Early Treatment Diabetic Retinopathy Study
Wisconsin Epidemiologic Study of Diabetic Retinopathy
Diabetic Retinopathy Vitrectomy Study
Fenofibrate Intervention and Event Lowering in Diabetes
Diabetic Retinopathy Clinical Research Network
United Kingdom Prospective Diabetes Study
Table 1. Studies (from 1970 to nowadays) about risk factors and natural history of DR.
DRS
ETDRS
WESDR
DRVS
FIELD
DRCR.net
UKPDS
important risk factors for the onset and progression of DR include longer diabetes duration, higher levels of glycated hemoglobin A1c [HbA1c] , male sex, and higher blood pressure. (9)
The studies that have investigated the risk factors and the natural history of DR from 1970 to the present are listed in Table 1.
Pathogenesis and classification
The pathogenesis of DR and DME is complex (Figure 1). Chronic hyperglycemia may activate metabolic pathways (e.g. polyol, protein kinase C, advanced glycosylation end products,

Figure 1. Summary of etiopathogenetic pathways in DR and DME (Courtesy of Yang Z et al. Front Endocrinol [Lausanne], 2022)
[AGEs]), cellular processes (oxidative stress), neuroinflammation, and the renin-angiotensin system. Increasing evidence indicates that the traditional view of DR as purely microvascular disease is inaccurate, since retinal neurodegeneration occurs concurrently or even precedes vascular damage in the early stages, without detectable DR. The imbalance between upregulated neurotoxic (e.g. glutamate) and downregulated neurotrophic (e.g. pigment epithelium-derived factor, PEDF) mediators lead to apoptosis and reactive gliosis, resulting in retinal ganglion cell layer (GCL) and nerve fiber layer (RNFL) thinning. To counteract this process, vascular endothelial growth factor (VEGF) and other mediators (erythropoietin, insulin-like growth factor, growth hormone, and angiopoietin) are overexpressed, linking neurodegeneration to neurovascular unit impairment and breakdown of the inner blood–retina barrier (BRB).
Early non-proliferative microvascular damage includes thickening of the basement membrane, disruptions of the tight junctions and loss of pericyte clinically corresponding to microaneurysms and intraretinal hemorrhages (dot, blot, flamed-shaped). Subsequently, hypoxia and capillary occlusion are favored by the predominance of vasoconstrictors agents and maladaptive vascular remodeling. Thus, severe NPDR displays retinal ischemia starting from periphery towards the macula (diabetic macular ischemia, [DMI]), retinal infarction (cotton wool spots), dilated capillaries and shunts between arteries and veins (intraretinal microvascular abnormalities, [IRMA]) and anomalous veins (dilated, tortuous and irregular in caliber). In late stages of PDR, the hypoxic environment creates an imbalance of angiogenic (e.g. VEGF) over anti-angiogenic (e.g. PEDF) mediators, resulting in neovascularization (NV) sprouting on the optic disc (NVD), the retina, the iris and the angle (neovascular glaucoma). Due to their structural weakness, these new vessels are more likely to bleed spontaneously (vitreous and preretinal hemorrhage), and adhere to the vitreous body. Over time, adventitial fibrotic component develops and contracts, forming epiretinal membranes (ERM), vitreomacular traction (VMT), and ultimately tractional retinal detachment. (2,3) Notably, DME may occur during both NPDR and PDR. DME manifests as retinal thickening due to the accumulation of intraretinal fluid and/or extracellular lipid leakage (hard exudates) in the outer plexiform layer. Several mechanisms, including VEGF, have been proposed, all converging on the internal breakdown of the BRB due to increased capillary permeability and vascular leakage (10) Additionally, vitr-
Disease severity level
No apparent DR (level 10)
Mild NPDR (level 20)
Moderate NPDR (levels 47-35)
Severe NPDR (1-2-4 rule) (level 53)
PDR (levels 85-60)
Findigns observable upon dilated ophthalmoscopy
No abnormalities
Microaneurysms only
More than just microaneurism, but less than severe NPDR:
– retinal hemorrhages;
– hard hexudates;
– cotton wool spots;
No signs of PDR & any of the following:
– ≥ 20 intraretinal hemorrhages in each of 4 quadrants;
– Definite venous beading in ≥ 2 quadrants;
– Prominent IRMA in ≥ 1 quadrant;
≥ 1 of following signs:
– Neovascularization;
– Vitreous/preretinal hemorrhages;
Table 2. International Clinical Diabetic Retinopathy (ICDR) severity scale of DR. (20) Abbreviations: IRMA intraretinal microvascular abnormalities; NPDR non-proliferative diabetic retinopathy; PDR proliferative diabetic retinopathy
eomacular interface abnormalities (ERM, VMT, and macular hole) may be detected in chronic DME. (11) Furthermore, diabetes may also impact on the choroidal vasculature (diabetic choroidopathy), mainly affecting the choriocapillaris by vascular dropout and vessel tortuosity. (12–14) Interestingly, alterations in the choroidal vasculature may precede the onset of DR. (15,16)
Several clinical classifications of DR and DME have been proposed. Color fundus photographs (CFP) have been used to classify DR since early grading systems (e.g. Hammersmith and Airlie House). (3) The ETDRS severity scale classified individual fundus lesions on stereoscopic 7-field 30° CFP, thereby quantifying the overall retinopathy severity in 14 levels (10-85). (17) Despite being “the gold standard” classification, its clinical use has been restricted to research settings due to its complexity. (18) The WESDR study group proposed an alternative system, assigning severity levels (1-7) based on the most severe DR across all 7 photographic fields. (19)
Today, the International Clinical Diabetic Retinopathy (ICDR) severity scale, developed from ETDRS and WESDR models and based on ophthalmoscopy, is the most commonly used classification in daily clinical practice (Table 2). (20)
Notably, DRS trial classified PDR as “high-risk”, as the patient, if not treated urgently, is at high risk of severe visual loss, based on presence of 3 of following features:
Neovascularization of disc (NVD) larger than one-third to one-fourth disc diameter;
NVD smaller than one-third to one-fourth disc diameter with vitreous/pre-retinal hemorrhage;
Neovascularization of elsewhere (NVE) with vitreous/pre-retinal hemorrhage (21,22)
Multimodal imaging findings and biomarkers
Traditionally, the gold-standard diagnostic methods for DR and DME were CFP and fluorescein angiography (FA). Recently, multimodal imaging approaches also revolutionized the diagnosis and management of DR and DME through application of non-invasive modalities, including OCT, OCT angiography (OCT-A), ultra-wide field (UWF) techniques (retinography, FA, OCT,

Figure 2. Multimodal imaging of right eye of a male diabetic patient affected by PDR and DME. 2A-B) UWF pseudocolor retinography (Optos Silverstone, Optos, UK) and corresponding magnification of macular region showing diffuse hard exudates and intraretinal hemorrages; 2C) OCT (Heidelberg Spectralis, Heidelberg Engineering Inc., Germany) displaying diffuse center-involving DME; 2D-E) Late phase UWF FA (Optos Silverstone, Optos, UK) and corresponding magnification of macular region presenting extense breakdown of BRB with perivascular leakage and non-perfusion areas, pooling effect compatible with MA and masking effect due to pre-retinal hemorrhages. Two leakage spots associated to possible NVs close to inferior vascular arcade; 2F) 3x3 B-scan OCT-A (Zeiss PLEX Elite 9000, Carl Zeiss, Germany) showing flow signal within pre-retinal NV.

Figure 3. Multimodal imaging of a male diabetic patient affected by PDR and DME that has already been treated by incomplete laser photocoagulation therapy. 3A) UWF pseudocolor retinography displaying hard exudates and intraretinal hemorrhages within vascular arcades and peripheral laser photocoagulation therapy; 3B) UWF SS-OCT showing focal center-involving DME; 3C) Late phase UWF FA (describing mild BRB disruption with 2 leakage areas compatible with NV along inferior vascular arcade; 3D) 15x15 En-face WF-SS-OCTA presenting FAZ enlargement, diffuse capillary drop-out and temporal mid-peripheral retinal nonperfusion areas, and two pathological vascular networks associated to NVs.

Figure 4. Multimodal imaging of a female diabetic patient affected by PDR that has already undergone complete laser photocoagulation treatment. 4A) UWF pseudocolor retinography showing complete laser photocoagulation treatment until vascular arcades; 4B-C) 12x12 and 4E-F) en-face WF-SS-OCTA of diabetic patient (4B, 4E) presenting FAZ enlargement, diffuse capillary drop-out and inferior mid-peripheral retinal nonperfusion areas, as compared to healthy patient (4C, 4F; 4D) Late phase UWF FA displaying diffuse BRB breakdwon, with perivascular leakage and non-perfusion areas.

5. Multimodal imaging of a
diabetic patient affected by
5A) UWF pseudocolor retinography showing some hard exudates within and outside vascular arcades; 5B) Late phase UWF FA presenting far peripheral BRB rupture, with associated perivascular leakage and retinal ischemia, and diffuse pooling effect within telengectasic vessels; 5C) UWF SS-OCT, displaying some hard exudates close to optic disc.
OCT-A) (Figures 2-5).
For many decades, color fundus photography has been crucial for the diagnosing and management of diabetic retinopathy. The ETDRS 7 standard fields protocol, considered the gold standard, uses a traditional fundus camera to capture 30° of the retinal surface at a time, combining seven images in fixed position (4 around the optic nerve, 3 across the macula). However, 7SF displayed several drawbacks, including the need of highly skilled operators and a fully collaborative patient, the necessary mydriasis, and the inability to simultaneously image the entire retina. (23) In addition, a single 45° CFP scan provides data from only 15% of the retinal surface area, whereas 7SF covers central 90° posteriori region, corresponding to less than 30% of the total retina. (24)
The pseudocolor UWF imaging provides a single-shot field of at least 110° field of view anterior to the vortex vein ampullae in all four quadrants, with no need of mydriasis or contact lenses. Nonetheless, many commercials systems capture up to 200°. (25) About 82% of the total retinal surface is detected, although photomontage may cover almost all retina. (26) UWF retinography has shown a substantial agreement in assessing DR severity, but with a higher detection rate (10%) compared to the 7SF gold-standard. (27) This increased sensitivity may be due to predominantly peripheral lesions (PPLs), corresponding to anomalies (e.g. retinal hemorrhage/MA, IRMA and NVE) located outside the 7SF in more than 30% cases. Among these lesions, hemorrhages/MA were predominant PPL. (28) The presence and extent of PPLs may show a prognostic significance, raising the risk of DR progression. In addition, UWF retinography reduces the percentage of ungradable images by more than 70% and decreases image assessment time by 25%. (29,30) Exploring the peripheral retina
employing UWF imaging may offer useful data for DR progression and classification. However, how this data might be integrated into a new DR classification remains unclear. (3)
Fluorescein angiography can detect different vascular manifestations of DR, such as microaneurysms (MAs), venous beading, BRB impairment, IRMAs, NVs and non-perfusion areas. Specifically, MAs appear as circular hyperfluorescent pinpoints both in the early and late FA phases. Blood–retinal barrier breakdown appears as a diffuse, late-stage hyperfluorescent signal consistent with leakage. IRMAs are tortuous intraretinal vascular abnormalities associated with minimal or no leakage on FA. Retinal NVs may be identified as hyperfluorescent regions with late-stage leakage. Therefore, FA alone may not be sufficient to distinguish small and faintly leaking NVs from IRMAs. Non-perfused regions appear as early hyperfluorescent areas surrounded by large hyperfluorescent retinal vessels. (31) The presence of DMI on FA images is defined as the presence of capillaries and/or arterioles alterations in the macular region, particularly in the fovea. (32) It is important to note that several studies employing FA have demonstrated that DMI tends to aggravate throughout the different stages of DR. (20)
Angiographic evaluation of peripheral retina plays a key role in the screening, diagnosis, treatment and prognosis of DR. (33) Wide-field and UWF fluorescein angiography systems have been employed to overcome diagnostic pitfalls of traditional FA, demonstrating several advantages. First, UWFA reveals more retinal surface, peripheral non-perfusion areas, NV, and panretinal photocoagulation (PRP) laser treatments. (34,35) Thus, UWF-FA may better predict DR progression compared to the 7SF, as increased non-perfusion areas on UWF-FA are associated with the presence of PPL. (36,37) Secondly, UWFA ha introduced new qualitative angiographic biomarkers, including white dots and peripheral vascular leakage (PVL). In detail, white dots represent capillary nonperfusion signs without angiographic evidence that have been linked to DR severity. (38) Additionally, UWFA has introduced new qualitative angiographic biomarkers, including white spots and peripheral vascular leakage (PVL). Specifically, white spots indicate areas of capillary non-perfusion without clear angiographic evidence, which have been linked to the severity of DR. (38) On UWFA, PVL corresponds to late leakage, reflecting impairment of BRB in the setting of acute DR. It has been postulated that VEGF upregulation may cause NV growth and BRB disruption both in macular and peripheral retina, leading to macular leakage and PVL, respectively. (39) UWFA introduced novel quantitative biomarkers, such as ischemic index (ISI), defined as ratio between nonperfused areas and total retinal surface, [48] and retinal vascular bed area (RVBA), which calculates area and density occupied by the vessels on binarized UWF-FA images. (40) ISI has been associated with the presence and severity of DME, (41,42) DMI, (43) recurrence of vitreous hemorrhage following vitrectomy (44) and oxygen saturation of retinal arteries. RVBA was found to be correlated with worsening DR severity and presence/absence of DME, but its role as a prognostic metric is unclear. (40) Other quantitative angiographic biomarkers include hemorrhages/MAs count. (45) UWFA also displays a role in DR therapeutic management. With UWFA it is possible to guide targeted laser photocoagulation (TRP) and selectively treat ischemic areas while sparing the perfused retina. For this reason TRP reduces common side effects of standard PRP (e.g. visual acuity reduction, visual field constriction), with similar efficacy in NV regression but less effect on CST. (46,47)
OCT allows the evaluation of a variety of quantitative and qualitative retinal biomarkers in DR and DME (Table 3). Quantitative parameters include central subfoveal thickness (CST) and macular volume. (48) However, the value of CST in a clinical setting is debated, since its cor-
Retinal quantitative parameters
CST Average thickness of the central 1 mm macula centred on the fovea
Macular volume
Retinal qualitative parameters
DRIL
ELM, EZ, IZ integrity
HRF
Average thickness in the 9 paracentral subfields (central subfield, 4 inner subfields and 4 outer subfields) divided by grid area
Indistinguishable boundaries between ganglion cell-inner plexiform layer complex, inner nuclear layer and outer plexiform layer. Assessed on the central 1000 μm
ELM, EZ and IZ are the first, second and third hyperreflective bands, respectively, of the four outer most layers on OCT. Integrity is assessed on the central 1000 μm
Circumscribed hyperreflective foci with similar reflectivity to the RPE layer, absence of back shadowing and <30 μm diameter. Located between the internal limiting membrane and retinal pigment epithelium. Number of HRF is manually counted within the 1500 μm of fovea
Choroidal quantitative parameters
Subfoveal choroidal thickness
CVI
Distance between outer edge of RPE to inner sclera in the subfoveal region
Ratio of luminal area to total circumscribed subfoveal choroidal area in the central 1.5 mm centred on fovea. It is calculated based on binarized OCT images into light and dark pixels
Choroidal quantitative parameters
HCF
Circumscribed hyperreflective foci with reflectivity equal to or higher than that of retinal pigment epithelium, located outer to the retinal pigment epithelium. Number of HCF is manually counted within the 1500 μm of fovea
Table 3. Summary of quantitative and qualitative retinal and choroidal OCT biomarker of DR and DME. (53)
Abbreviations: CST: central subfield thickness; CVI: choroidal vascularity index; DRIL: disorganization of retinal inner layers; ELM: external limiting zone; EZ: ellipsoid zone; HCF: hyperreflective choroidal foci; HRF: hyperreflective retinal foci; IZ: interdigitation zone.
relation with low VA is surprisingly low. (49) A reduction of RNFL and GCL was described in patients affected by DR, as well as in diabetic patients before onset of DR, compared with healthy controls. (48) This biomarker is thought to express diabetic retinal neurodegeneration. (50–52) Conversely, qualitative features are the disorganization of retinal inner layers (DRIL), the disruption of photoreceptors layers such as external limiting membrane (ELM),ellipsoid zone (EZ),interdigitation zone (IZ), and intraretinal hyper-reflective foci (HRF). (53) Some of these tomographic parameters showed prognostic value. HRF (54) and DRIL (55) have been associated with an increase in the progression of DR. Conversely, disruption of ELM (56) and EZ (57) have been related to visual acuity outcomes. Notably, some groups proposed OCT-based classification systems for DME. (58,59)
The European School for Advanced Studies in Ophthalmology (ESASO) classified DME in 4 stages (early, advanced, severe DME and atrophic maculopathy) based on seven OCT quantitative/qualitative biomarkers (TCED-HFV protocol) (Table 4), suggesting a possible progression through different stages of severity. (58)
Beyond diabetic maculopathy, OCT reveals several lesions occurring in the setting of either NPDR (e.g. hard exudates, MA, cotton-wool spots) or PDR (e.g. NV, hemorrhage). (23) Furthermore, subfoveal choroidal thickness (SFCT), choroidal vascularity index (CVI) and hyperreflective choroidal foci (HCF) are imaging markers of diabetic choroidopathy. Conflicting evidence
Thickening (T)
Cysts (C)
EZ and/or ELM status (E)
DRIL (D)
Hyperreflective foci (H)
Subretinal fluid (F)
Vitreoretinal relationship (V)
0 Less than %10 increase above upper normal values
1 More than %10 but less than %30 increase above upper normal values
2 More than %30 increase above upper normal values
0 Absent
1 Mild
2 Moderate
3 Severe
0 Intact
1 Disrupted
2 Absent
0 Absent
1 Present
30 < 0
30 < 1
0 Absent
1 Present
0 Absence of any visivle adhesion or traction between vitreous cortex and retina
1 IVD
2 PVD
3 VMT
4 ERM
Table 4. ESASO OCT-based grading (TCED-HFV protocol) of DME (58) Abbreviations: EZ: ellipsoid zone; ELM: external limiting membrane; DRIL: disorganization of the inner retinal layers; IVD: incomplete posterior vitreous detachment; PVD: posterior vitreous detachment; VMT: vitreomacular traction; ERM: epiretinal membrane.
reported both reduced and increased choroidal thickness in relation to DR and DME severity. (53) CVI may be more compromised in advanced stages of DR and based on different topographic distributions (macular and peripheral), with lower values in macular regions than mid-peripheral regions. (60)
Little evidence about retinal and choroidal anomalies in DR has been produced using UWF SS-OCT. Approximately 24% of IRMA has been found to be NVE, whereas 9% of NVE was found in uncommon areas. Overall, 25% of eyes reported a change in DR severity.. (61) Diabetic choroidopathy was assessed over different DR stages in terms of choroidal vascular index, comparing these calculations with corresponding on SS-OCT. By comparing agreement between two devices in CVI values, a fair correlation was found between macular measurements, but caution was recommended in extreme CVI assessment. (60) Further studies are required to expand current literature on this novel modality.
OCT-A grants in-vivo depth-resolved images of retinal and choroidal vessels, which provide additional diagnostic information over FA. (62,63) OCT-A detects capillary abnormalities (non-perfusion areas, MA, IRMA), venous loop, and NV. (64–69) Retinal nonperfusion may be suspected as well-defined hyporeflective regions surrounded by irregular capillaries. Inter-
estingly, detection rate of non-perfusion areas is higher on OCT-A than FA (64), but similar to values of UWF-FA. (70) OCT-A permits identification and characterization of MA that FA would not reveal. (66) As compared to FA, OCT-A efficiently discriminates between IRMA or NV, based on their topography. In details, while IRMA is totally localized within ischemic retinal regions, NV protrudes into the vitreous. (66,67) OCT angiography may differentiate NV activity according to its morphology. (69) OCT-A parameter of non-perfusion is traditionally the morphology of foveal avascular zone (FAZ), that in diabetic patients is usually enlarged and irregular due to ischemic damage. Conflicting evidence debates about which retinal capillary plexus is primarily affected. (71,72) Nonetheless, wide variability in FAZ size among healthy and diabetic subjects has limited its accuracy in DR. (15) For this reason, several quantitative metrics of retinal perfusion have been introduced, including vessel density (VD), vessel length density (VLD), vessel tortuosity (VT), fractal dimension (FD). (70,73) To provide a better representation on OCT-A of ischemia, several authors proposed a threshold to identify hypoxic tissue, based on distance to the nearest blood vessel (geographic perfusion deficit, [GPD]). (74) Recently, GPD did correlate better with the nonperfusion on UWF-FA, and both these imaging modalities were comparable in detecting clinically referable DR. (70) OCT-A displayed a CC impairment in DR that has been associated with outer damages. (75)
OCT-A has been advocated as screening test to detect early microcirculatory disturbances (FAZ anomalies, reduced VD) in diabetic patient with no detectable DR. (76,77)
Many of these quantitative parameters have related to stage of DR and probability of progression in manifest DR and DME. (78) As examples, both FAZ area and VD have been correlated to visual acuity, (79,80) whereas an higher CC flow deficit has associated to DR progression. (81) Several artifacts could affect this modality: OCT-A devices are limited in the detection of flow, which is slower than a specific threshold (“undetectable flow”). To overcome this limitation, a variable interscan time analysis (VISTA) algorithm was developed. (71) Similarly, flattening the data in a segmented two-dimensional volume may result in flow overestimation, and thus misinterpretation of diabetic vascular anomalies (MA).
WF swept-source OCT-A (WF SS-OCT-A) has been employed in the assessment of DR. Although WF-OCTA has significantly expanded the field of view of macular OCT-A using montage, the detected area is smaller than other UWF modalities (80% vs. 110-200%) that still represent the gold-standard in diagnostic techniques. (40,72) WF-OCT-A provided some advantages in identification of neovascularizations and non-perfusion areas in comparison to other UWF techniques. In details, NV detection rate was similar or higher (>95%) than UWFA independent of reader because of vitreoretinal interface slab, (82-86) despite contrasting evidences. (87,88) Areas of nonperfusion detection on UWF-FA co-localized with areas of nonperfusion on WF-OCTA, although the latter detected significantly greater ischemia. (89,90) Some authors demonstrated the utility of combining different UWF technologies (OCT, OCT-A, retinography), with reported superior results. (91,92) Furthermore, quantitative biomarkers of early retinal and choroidal involvement in diabetic patients have been calculated by using WF-OCT-A, including SCP VD (93) and mid-stromal VD (94,95). UWF OCT-A also provided new qualitative biomarker of peripheral retinal ischemia, including retinal venous loops. (96) A recent staging system based on WFSS-OCT-A included subclinical alterations (reduced VD) together with traditional DR vascular anomalies (MA, areas of non-capillary perfusion, venous beading, IRMA), also differentiating among active and quiescent NV. (97)
Articial intelligence (AI)
Deep learning (DL) is an innovative AI-based method, combining multiple processing networks (“brain”) to associate input datasets (“dictionary”) with diagnostic output (classification, pre-
dictions). (98) DL has been adopted by several groups to develop algorithms for automated DR diagnosis and screening. Different imaging modalities have been employed, including CFP, (99,100) UWF retinography, (101) and OCTA images (72,102). Certain DL algorithms are already in clinical use, after regulatory approval by FDA (103–105). Of note, a recent DL machine reported significantly higher sensitivity than ophthalmoscopic diagnosis (96% vs 60%) (105), whereas previous AI-based classifiers were support tools, requiring expertise for labeling at pixel level. The new DR classification system could accept AI-based grading in research and clinical practice to improve prognostication of patient outcomes. AI could be used to automate lesion quantification and counting processes. Significant barriers still remain in this area, since developing and validating robust AI algorithms requires good longitudinal datasets. (3)
Despite international recommendations, current efforts for DR screening are not enough for growing needs of the increasing diabetic population. (6) Ocular telehealth programs (teleophthalmology) rely on the acquisition of retinal images based on a store-and-forward approach. (106) A common approach is the two-field 45° digital CFP, although UWF retinal imaging has emerged, to identify otherwise missing peripheral lesions that may indicate more severe DR. (107) However, these imaging devices are still not widely used globally due to their high cost, lack of portability, and the need for technical expertise. Therefore, novel hybrid telemedicine systems have widely spread in particular in rural/developing areas. (108) Among these low-cost imaging devices, hand-held, portable fundus cameras and smartphone-based retinal imaging are included. (109,110) Although these telemedicine methods are effective in detecting DR, they are not substitutes for comprehensive fundus examinations. (111)
Remote monitoring: in-home testing
Remote monitoring technologies (e.g. investigational home OCT) have been developed as a complementary monitoring strategy outside of hospitals for chronic macular diseases. These systems are based on self-measuring OCT devices, digital data transmission platforms, and DL algorithms. Data supports its clinical application in DME. (112,113) The use of mobile devices has fueled the rise of remote healthcare, improving DME in terms of VA and treatment discontinuity. (114) Although in-home testing could increase cost-effective surveillance, safety and efficacy of this approach in DR care need further research. (115)
Although traditional approaches in DR focused on tertiary prevention (therapeutic management), primary (risk factors control) and secondary (periodic screening) prevention strategies are becoming increasingly important to intercept the disease in its early stages. The goal of
Diabetes type
Recommended initial evaluation Recommended follow-up
Diabetes type 1 5 years after diagnosis Yearly
Diabetes type 2 At time of diagnosis Yearly
Pregnancy (type 1 or 2) Soon after conception and early in the first trimester – No DR-moderate NPDR: every 12-3 months – Severe NPDR or worse: every 3-1 months
Table 5. Recommendation for DR screening in Italy. (4) Abbreviations: DR: diabetic retinopathy; NPDR: nonproliferative diabetic retinopathy. 1 Women who develop gestational diabetes do not require eye examination during pregnancy and do not appear to be at increased risk for DR during pregnancy.
screening is to ascertain and classify the presence and classify DR, then refer patients to second-level diagnostic tests and treatments. (116) In 2018, International Council of Ophthalmology (ICO) guidelines indicated that DR screening must necessarily include: – visual acuity and refraction evaluations on standard near and far vision charts; – fundus oculi examination on ophthalmoscopy (direct/indirect), dilated slit-lamp biomicroscopy, retinography. (117)
A lower number of central fields provided non-inferior sensitivity to that of gold standard 7SF ETDRS. (118,119) The use of OCT and FA is not recommended as DR screening, but only as second-level tests. Although the UWF field is an excellent method for the detection of peripheral lesions, the high cost of cameras is still a great limitation. (27) Recently, innovative devices have been developed for cost-effective DR screening (see Telemedicine paragraph).
Recommendations for DR screening frequency are based on type of diabetes, and pregnancy status (Table 5). (4)
Therapeutic management of DR and DME include laser therapy, intravitreal injections of anti-VEGF agents and short/long-acting corticosteroid implants, surgery (pars plana vitrectomy [PPV]). Selecting the appropriate treatment option should be individually tailored through a discussion with the patient. Table 6 summarizes treatment options and follow-up recommendations based on severity of DR. (4)
Pills of therapeutic options
Different types of lasers have been used in DR, mostly argon green (514 nm) or dye yellow (577 nm). (120) Innovative technologies (e.g. micropulse diode laser) have been proposed to selec-
Table 6. Summarizes treatment options and follow-up recommendations based on severity
tively target retinal pigment epithelium, sparing surrounding tissue. (121) Nowadays, common clinical practice relies on the pattern scan laser (PASCAL) system, (122) especially if guided by UWF imaging (Navilas). (123) Several trials provided rationale for its use in this setting. Briefly, DRS demonstrated that PRP significantly reduced the risk of severe visual loss in eyes with PDR, compared with no treatment. (21) ETDRS proved superiority of early than deferred PRP in terms of functional and anatomic outcomes. (124) Long-term reports showed that long-lasting effectiveness of PRP treatment is dose related. (120) Advantages of laser are fewer costs, long-lasting effects, and lower risks of intravitreal injection-related complication (endophthalmitis) and systemic exposure. Laser-associated complications are progressive restriction of visual field, and vision anomalies (color, night, contrast sensitivity impairment). Furthermore, an increased rate of subretinal fibrosis, choroidal neovascularization, vitreous hemorrhage, DME worsening, and epiretinal membrane formation have been reported. (125)
Among VEGF-A inhibitors that have been traditionally employed in DR management there were pegaptanib, ranibizumab, bevacizumab, and aflibercept. (126) Brolucizumab and faricimab have been recently introduced. Brolucizumab is a single-chain low-weighted monoclonal antibody that binds to VEGF-A, providing durability and potential advantages over other anti-VEGF agents. (127) Brolucizumab is administered with a recommended dosage of 3 mg or 6 mg. Faricimab is a monoclonal antibody with immunoglobulin-like structure inhibiting both angiopoietin-2 (Ang-2) and VEGF-A. (128) This unique molecular structure leads to longer duration of action than other antiangiogenic drugs, allowing less frequent dosing schedule and quicker fluid resolution. (129) Overall, anti-VEGF therapy showed a favorable tolerability profile. However, an increased risk of tractional retinal detachment due to fibrosis was described in cases of coexisting DR and DME. Disadvantages of antiangiogenic agents are shorter duration of action, higher recurrence of disease requiring frequent treatments, with increased risk of adverse events (e.g. endophthalmitis, retinal tears and holes, vitreous hemorrhage). Moreover, anti-VEGF should be avoided in patients with cardiovascular disease, for increased risk of thromboembolic accidents. (126)
In DME management, triamcinolone acetonide, biodegradable dexamethasone (Ozurdex ®, AbbVie, USA), and not biodegradable fluocinolone acetonide (Iluvien ®, Alimera Sciences Inc, USA) implants have been employed, displaying differences in duration of action (from nearly a month to 3 years) and their relative potency (triamcinolone=5, dexamethasone=25, fluocinolone=25, compared to cortisol). (130) It was shown that corticosteroids may exert a neuroprotective effect on the retina, in addition to an anti-inflammatory function. (131,132) Most significant side effects of steroids are increased intraocular pressure and the progression of cataract.
DME therapeutic management
Therapeutic management of DME varies depending on whether the central macula is involved (CI-DME) or not (NCI-DME).
Several high-quality clinical trials supported use of intravitreal anti-VEGF as a first-line therapy in focal/diffuse CI-DME. (133–141) Interestingly, this requires a visual acuity (VA) loss of 20/32 or worse. (140,142) Conversely, in eyes with higher VA, treatment is reasonably deferred. (133) Possible loading-phase schedules include monthly or treat-and-extent schemes, with comparable visual and anatomic results. (143) Anti-VEGF agents employed in DME are bevacizumab, ranibizumab, aflibercept and, more recently, brolucizumab and faricimab (angiopoietin-2 and VEGF-A inhibitor). In detail, bevacizumab, ranibizumab, and aflibercept, demonstrated similar effectiveness and a comparable safety profile in CI-DME. Of note, in eyes with VA lower than 20/40, aflibercept provided a better functional response, compared to eyes with higher VA which show no outcome difference based on agents. (144) Recently, high-dose formulation of
aflibercept (8 mg) offered a control of DME progression similar to low-dose aflibercept (2 mg) but with longer treatment intervals, fewer injections, and a similar safety profile. (145) However, a significant proportion of DME cases (15–20%) does not adequately respond to anti-VEGF medication (persistent DME), (146) mainly after bevacizumab (57%) and ranibizumab (40%) injections. (147) Switching to a different medication (alternative anti-VEGF drug, corticosteroid) is a viable and essential option in these cases, (148,149) since a delay in treatment can negatively impact on VA. (150) Recently, it was shown non-inferiority of brolucizumab (mostly at dose of 6 mg) to aflibercept in DME management, in terms of functional and morphological outcomes in short (151) and long-term period. (152). Nonetheless, brolucizumab was associated with instances of retinal vasculitis, vascular occlusion, and intraocular inflammation (iritis, uveitis), mainly at a 3 mg dose. (153) Fortunately, in DME brolucizumab showed safer results than age-related macular degeneration (154) Recent clinical trials demonstrated the non-inferiority of faricimab compared to standard aflibercept (2 mg) in terms of efficacy (anatomic and visual outcomes) and safety; with the added benefit of an extension in the dosing intervals. (155,156) Evidences recommend this drug in DME patients who are unresponsive to other anti-VEGF inhibitors (e.g. aflibercept). (157)
Patients with persistent DME despite anti-VEGF therapy may undergo laser treatment. (141) In DME, the mechanism of action of the laser may be directed to either individual (focal laser) or diffuse (grid laser) leakage points. A modified ETDRS laser treatment is currently recommended, including less intense treatment (greater spacing than for a grid), targeting microaneurysms and sparing foveal vasculature (within central 500 μm). (158) Interestingly, both conventional photocoagulation and focal laser treatments improved VA, achieving partial/complete anatomic resolution. (159) Conversely, micropulse laser treatment reported less retinal damage with no visual differences, compared to conventional laser photocoagulation. (160)
Intravitreal corticosteroids implants in DME management are generally used as second-line agents, because of the aforementioned side-effects. (138,141,161) Importantly, this option is indicated for pseudophakic patients at slow risk for glaucoma or with a significant cardiovascular risk. No additional benefit of combined intravitreal anti-VEGF and steroid therapy over anti-VEGF monotherapy was reported. (162)
Laser photocoagulation is recommended as first-line option in focal NCI-DME without sign of vitreoretinal interface disorder, since anti-VEGF role has not been clarified yet. (158) In unresponsive cases to either laser photocoagulation and/or anti-VEGF therapy, the following step in the therapeutic algorithm is PPV associated with internal limiting membrane removal, particularly in eyes affected by vitreoretinal interface disorder. (163)
Therapeutic management of DR is based on clinical severity. In detail, absence of DR and mild/moderate DR may be followed-up, depending on the stage of the disease. (164)
Severe NPDR and non-high-risk PDR should undergo photocoagulation therapy. (120) Interestingly, prompt rather than deferred PRP is highly recommended in type 2 diabetic patients. (165) Full PRP is a proven treatment approach, whereas partial or limited PRP treatment is not indicated. (21)
Since evidence proved non-inferiority of anti-VEGF agents (ranibizumab, aflibercept) to laser photocoagulation, high-risk PDR may be addressed to PRP or intravitreal anti-VEGF therapy considering patient compliance. (166) While, intravitreal therapy reduced the onset of macular edema and a constriction of peripheral field compared to the laser-treated group, anti-VEGF injections alone could be recommended for patients with a reliable follow up. (167) Interestingly, aflibercept showed the highest severity improvements among antiangiogenic agents. (168)
Additional laser or intravitreal antiangiogenic treatment should be considered in the following scenarios: failure of NV regression; increasing NV of retina or iris; new vitreous hemorrhage; new areas of neovascularization. In such cases, anti-VEGF therapy and PRP may be performed concomitantly, especially with a concurrent CI-DME. PPV is reserved for refractory cases, or in DR not candidate to medical management. Typical indications for vitrectomy include nonclearing hemorrhage (vitreous/ pre-macular subhyaloid) and retinal detachments (tractional/rhegmatogenous) interfering with vision or treatment. Early surgery (within 6 months) demonstrated improved outcomes compared with late PPV. (169) Interestingly, pre/intra-operative anti-VEGF therapy did improve surgical outcomes (short surgical duration, fewer retinal breaks, fewer intra/post-operative vitreous hemorrhage). (170)
New therapeutic options for DR and DME targeting novel pathways are currently under evaluation. In addition to VEGF and ang2, VEGF receptor tyrosine kinase inhibitor (vorolanib, axitinib) and integrin antagonists (risuteganib, volociximab, THR-687, AG-73305) are also currently under investigation. Notably, gene therapy has also recently gained attention as a possible treatment for DR. (171) In details, RGX-314 (REGENXBIO Inc.) has been designed to induce retinal cells expression of anti-VEGF antibodies via a single subretinal or suprachoroidal injection. A phase II clinical trial is testing safety of suprachoroidal RGX-314 in DR, with encouraging preliminary findings. Interestingly, recent trials are studying alternatives to intravitreal regimens, such as innovative eye-drop and oral systemic treatments. (172)
Conclusion
Over the next years, global prevalence of DR is expected to invariantly increase, parallelly to its social and economic burden. The growing adoption of novel multimodal imaging biomarkers combined with technological innovations (teleophthalmology and artificial intelligence) could lead to a significant progress in the prevention and management of diabetic patients. Due to its complex pathogenesis and chronic course, there is no doubt that the treatment of DR should not be limited to a single option and need to be patient-tailored based on individual ocular and systemic risk factors. Novel promising drugs and therapy protocols are under investigations to address unresolved clinical issues and to ensure an economically sustainable management of this pathology.
Bibliography
1. Lin KY, Hsih WH, Lin YB, Wen CY, Chang TJ. Update in the epidemiology, risk factors, screening, and treatment of diabetic retinopathy. J Diabetes Investig. 2021;12(8).
2. Wong TY, Cheung CMG, Larsen M, Sharma S, Simó R. Diabetic retinopathy. Nat Rev Dis Primers. 2016 Mar 17;2.
3. Yang Z, Tan TE, Shao Y, Wong TY, Li X. Classification of diabetic retinopathy: Past, present and future. Vol. 13, Frontiers in Endocrinology. 2022.
4. Flaxel CJ, Adelman RA, Bailey ST, Fawzi A, Lim JI, Vemulakonda GA, et al. Diabetic Retinopathy Preferred Practice Pattern®. Ophthalmology. 2020;127(1).
5. Sun H, Saeedi P, Karuranga S, Pinkepank M, Ogurtsova K, Duncan BB, et al. IDF Diabetes Atlas: Global, regional and country-level diabetes prevalence estimates for 2021 and projections for 2045. Diabetes Res Clin Pract. 2022;183.
6. Teo ZL, Tham YC, Yu M, Chee ML, Rim TH, Cheung N, et al. Global Prevalence of Diabetic Retinopathy and Projection of Burden through 2045: Systematic Review and Meta-analysis. Ophthalmology. 2021;128(11).
7. Vujosevic S, Midena E. Diabetic Retinopathy in Italy: Epidemiology Data and Telemedicine Screening Programs. Vol. 2016, Journal of Diabetes Research. 2016.
8. Abou Taha A, Dinesen S, Vergmann AS, Grauslund J. Present and future screening programs for diabetic retinopathy: a narrative review. Vol. 10, International Journal of Retina and Vitreous. 2024.
9. Mellor J, Jeyam A, Beulens JWJ, Bhandari S, Broadhead G, Chew E, et al. Role of Systemic Factors in Improving the Prognosis of Diabetic Retinal Disease and Predicting Response to Diabetic Retinopathy Treatment. Vol. 4, Ophthalmology Science. 2024.
10. Das A, McGuire PG, Rangasamy S. Diabetic Macular Edema: Pathophysiology and Novel Therapeutic Targets. Vol. 122, Ophthalmology. 2015.
11. Ophir A, Martinez MR, Mosqueda P, Trevino A. Vitreous traction and epiretinal membranes in diabetic macular oedema using spectral-domain optical coherence tomography. Eye. 2010;24(10).
12. Hidayat AA, Fine BS. Diabetic Choroidopathy: Light and Electron Microscopic Observations of Seven Cases. Ophthalmology. 1985;92(4).
13. Fryczkowski AW, Hodes BL, Walker J. Diabetic choroidal and iris vasculature scanning electron microscopy findings. Int Ophthalmol. 1989;13(4).
14. Fryczkowski AW, Sato SE, Hodes BL. Changes in the diabetic choroidal vasculature: scanning electron microscopy findings. Ann Ophthalmol. 1988;20(8).
15. Nesper PL, Roberts PK, Onishi AC, Chai H, Liu L, Jampol LM, et al. Quantifying microvascular abnormalities with increasing severity of diabetic retinopathy using optical coherence tomography angiography. Invest Ophthalmol Vis Sci. 2017;58(6).
16. Choi W, Waheed NK, Moult EM, Adhi M, Lee B, De Carlo T, et al. Ultrahigh speed swept source optical coherence tomography angiography of retinal and choriocapillaris alterations in diabetic patients with and without retinopathy. Retina. 2017;37(1).
17. Grading Diabetic Retinopathy from Stereoscopic Color Fundus Photographs — An Extension of the Modified Airlie House Classification: ETDRS Report Number 10. Ophthalmology. 2020;127(4).
18. Fundus Photographic Risk Factors for Progression of Diabetic Retinopathy: ETDRS Report Number 12. Ophthalmology. 1991;98(5).
19. Klein R, Klein BEK, Magli YL, Brothers RJ, Meuer SM, Moss SE, et al. An Alternative Method of Grading Diabetic Retinopathy. Ophthalmology. 1986;93(9).
20. Wilkinson CP, Ferris FL, Klein RE, Lee PP, Agardh CD, Davis M, et al. Proposed international clinical diabetic retinopathy and diabetic macular edema disease severity scales. Ophthalmology. 2003;110(9).
21. Indications for photocoagulation treatment of diabetic retinopathy: Diabetic Retinopathy Study Report no. 14. The Diabetic Retinopathy Study Research Group. Int Ophthalmol Clin. 1987;27(4).
22. Photocoagulation Treatment of Proliferative Diabetic Retinopathy: The Second Report of Diabetic Retinopathy Study Findings. Ophthalmology. 1978 Jan 1;85(1):82–106.
23. Battaglia Parodi M, Cicinelli MV, Rabiolo A. Diabetic Retinopathy: Essentials for Fast Diagnosis, Prognosis and Choice of Treatment. In 2017.
24. Byberg S, Vistisen D, Diaz L, Charles MH, Hajari JN, Valerius M, et al. Optos wide-field imaging versus conventional camera imaging in Danish patients with type 2 diabetes. Acta Ophthalmol. 2019;97(8).
25. Choudhry N, Duker JS, Freund KB, Kiss S, Querques G, Rosen R, et al. Classification and Guidelines for Widefield Imaging: Recommendations from the International Widefield Imaging Study Group. Ophthalmol Retina. 2019;3(10).
26. Singer M, Sagong M, Van Hemert J, Kuehlewein L, Bell D, Sadda SR. Ultra-widefield Imaging of the Peripheral Retinal Vasculature in Normal Subjects. Ophthalmology. 2016;123(5).
27. Silva PS, Cavallerano JD, Sun JK, Soliman AZ, Aiello LM, Aiello LP. Peripheral lesions identified by mydriatic ultrawide field imaging: Distribution and potential impact on diabetic retinopathy severity. Ophthalmology. 2013;120(12).
28. Aiello LP, Odia I, Glassman AR, Melia M, Jampol LM, Bressler NM, et al. Comparison of Early Treatment Diabetic Retinopathy Study Standard 7-Field Imaging with Ultrawide-Field Imaging for Determining Severity of Diabetic Retinopathy. JAMA Ophthalmol. 2019;137(1).
29. Silva PS, Cavallerano JD, Tolls D, Omar A, Thakore K, Patel B, et al. Potential efficiency benefits of nonmydriatic ultrawide field retinal imaging in an ocular telehealth diabetic retinopathy program. Diabetes Care. 2014;37(1).
30. Ghasemi Falavarjani K, Tsui I, Sadda SR. Ultra-wide-field imaging in diabetic retinopathy. Vision Res. 2017 Oct 1;139:187–90.
31. Lee CS, Lee AY, Sim DA, Keane PA, Mehta H, Zarranz-Ventura J, et al. Reevaluating the definition of intraretinal microvascular abnormalities and neovascularization elsewhere in diabetic retinopathy using optical coherence tomography and fluorescein angiography. Am J Ophthalmol. 2015;159(1).
32. EARLY TREATMENT DIABETIC RETINOPATHY STUDY RESEARCH GROUP. Classification of Diabetic Retinopathy from Fluorescein Angiograms: ETDRS Report Number 11. Ophthalmology. 1991;98(5):807–22.
33. Soliman AZ, Silva PS, Aiello LP, Sun JK. Ultra-wide field retinal imaging in detection, classification, and management of diabetic retinopathy. Vol. 27, Seminars in Ophthalmology. 2012.
34. Friberg TR, Gupta A, Yu J, Huang L, Suner I, Puliafito CA, et al. Ultrawide angle fluorescein angiographic imaging: A comparison to conventional digital acquisition systems. Ophthalmic Surgery Lasers and Imaging. 2008;39(4).
35. Wessel MM, Aaker GD, Parlitsis G, Cho M, D’Amico DJ, Kiss S. Ultra-wide-field angiography improves the detection and classification of diabetic retinopathy. Retina. 2012;32(4).
36. Marcus DM, Silva PS, Liu D, Aiello LP, Antoszyk A, Elman M, et al. Association of Predominantly Peripheral Lesions on Ultra-Widefield Imaging and the Risk of Diabetic Retinopathy Worsening over Time. JAMA Ophthalmol. 2022;140(10).
37. Silva PS, Marcus DM, Liu D, Aiello LP, Antoszyk A, Elman M, et al. Association of Ultra-Widefield Fluorescein Angiography-Identified Retinal Nonperfusion and the Risk of Diabetic Retinopathy Worsening over Time. JAMA Ophthalmol. 2022;140(10).
38. Dodo Y, Murakami T, Unoki N, Ogino K, Uji A, Yoshitake S, et al. White dots as a novel marker of diabetic retinopathy severity
in ultrawide field imaging. PLoS One. 2016;11(11).
39. Oliver SCN, Schwartz SD. Peripheral Vessel Leakage (PVL): A new angiographic finding in diabetic retinopathy identified with ultra wide-field fluorescein angiography. Semin Ophthalmol. 2010;25(1–2).
40. Ashraf M, Cavallerano JD, Sun JK, Silva PS, Aiello LP. Ultrawide field imaging in diabetic retinopathy: Exploring the role of quantitative metrics. Vol. 10, Journal of Clinical Medicine. 2021.
41. Patel RD, Messner L V., Teitelbaum B, Michel KA, Hariprasad SM. Characterization of ischemic index using ultra-widefield fluorescein angiography in patients with focal and diffuse recalcitrant diabetic macular edema. Am J Ophthalmol. 2013;155(6).
42. Wessel MM, Nair N, Aaker GD, Ehrlich JR, D’Amico DJ, Kiss S. Peripheral retinal ischaemia, as evaluated by ultra-widefield fluorescein angiography, is associated with diabetic macular oedema. British Journal of Ophthalmology. 2012;96(5).
43. Sim DA, Keane PA, Rajendram R, Karampelas M, Selvam S, Powner MB, et al. Patterns of peripheral retinal and central macula ischemia in diabetic retinopathy as evaluated by ultra-widefield fluorescein angiography. Am J Ophthalmol. 2014;158(1).
44. Kim DY, Kim JG, Kim YJ, Joe SG, Lee JY. Ultra-widefield fluorescein angiographic findings in patients with recurrent vitreous hemorrhage after diabetic vitrectomy. Invest Ophthalmol Vis Sci. 2014;55(11).
45. Guduru A, Martz TG, Waters A, Kshirsagar A V., Garg S. Oxygen saturation of retinal vessels in all stages of diabetic retinopathy and correlation to ultra-wide field fluorescein angiography. Invest Ophthalmol Vis Sci. 2016;57(13).
46. Muqit MMK, Marcellino GR, Henson DB, Young LB, Patton N, Charles SJ, et al. Optos-guided pattern scan laser (Pascal)-targeted retinal photocoagulation in proliferative diabetic retinopathy. Acta Ophthalmol. 2013;91(3).
47. Muqit MMK, Young LB, McKenzie R, John B, Marcellino GR, Henson DB, et al. Pilot randomised clinical trial of Pascal TargETEd Retinal versus variable fluence PANretinal 20 ms laser in diabetic retinopathy: PETER PAN study. British Journal of Ophthalmology. 2013;97(2).
48. Carpineto P, Toto L, Aloia R, Ciciarelli V, Borrelli E, Vitacolonna E, et al. Neuroretinal alterations in the early stages of diabetic retinopathy in patients with type 2 diabetes mellitus. Eye (Basingstoke). 2016;30(5).
49. Deák GG, Schmidt-Erfurth UM, Jampol LM. Correlation of Central Retinal Thickness and Visual Acuity in Diabetic Macular Edema. Vol. 136, JAMA Ophthalmology. 2018.
50. Sohn EH, Van Dijk HW, Jiao C, Kok PHB, Jeong W, Demirkaya N, et al. Retinal neurodegeneration may precede microvascular changes characteristic of diabetic retinopathy in diabetes mellitus. Proc Natl Acad Sci U S A. 2016;113(19).
51. Vujosevic S, Midena E. Retinal layers changes in human preclinical and early clinical diabetic retinopathy support early retinal neuronal and müller cells alterations. J Diabetes Res. 2013;2013.
52. Ng DSK, Chiang PPC, Tan G, Cheung CMG, Cheng CY, Cheung CY, et al. Retinal ganglion cell neuronal damage in diabetes and diabetic retinopathy. Clin Exp Ophthalmol. 2016;44(4).
53. Szeto SK, Lai TY, Vujosevic S, Sun JK, Sadda SVR, Tan G, et al. Optical coherence tomography in the management of diabetic macular oedema. Vol. 98, Progress in Retinal and Eye Research. 2024.
54. Vujosevic S, Bini S, Midena G, Berton M, Pilotto E, Midena E. Hyperreflective intraretinal spots in diabetics without and with nonproliferative diabetic retinopathy: An in vivo study using spectral domain OCT. J Diabetes Res. 2013;2013.
55. Das R, Spence G, Hogg RE, Stevenson M, Chakravarthy U. Disorganization of inner retina and outer retinal morphology in diabetic macular edema. JAMA Ophthalmol. 2018;136(2).
56. Muftuoglu IK, Mendoza N, Gaber R, Alam M, You Q, Freeman WR. INTEGRITY of OUTER RETINAL LAYERS after RESOLUTION of CENTRAL INVOLVED DIABETIC MACULAR EDEMA. Retina. 2017;37(11).
57. Zur D, Iglicki M, Busch C, Invernizzi A, Mariussi M, Loewenstein A, et al. OCT Biomarkers as Functional Outcome Predictors in Diabetic Macular Edema Treated with Dexamethasone Implant. Ophthalmology. 2018;125(2).
58. Panozzo G, Cicinelli MV, Augustin AJ, Battaglia Parodi M, Cunha-Vaz J, Guarnaccia G, et al. An optical coherence tomography-based grading of diabetic maculopathy proposed by an international expert panel: The European School for Advanced Studies in Ophthalmology classification. Eur J Ophthalmol. 2020;30(1).
59. Otani T, Kishi S, Maruyama Y. Patterns of diabetic macular edema with optical coherence tomography. Am J Ophthalmol. 1999;127(6).
60. Nicolini N, Tombolini B, Barresi C, Pignatelli F, Lattanzio R, Bandello F, et al. Assessment of Diabetic Choroidopathy Using Ultra-Widefield Optical Coherence Tomography. Transl Vis Sci Technol. 2022;11(3).
61. Ashraf M, Sun JK, Silva PS, Aiello LP. Using Ultrawide Field-Directed Optical Coherence Tomography for Differentiating Nonproliferative and Proliferative Diabetic Retinopathy. Transl Vis Sci Technol. 2023;12(2).
62. Borrelli E, Sarraf D, Freund KB, Sadda SR. OCT angiography and evaluation of the choroid and choroidal vascular disorders. Vol. 67, Progress in Retinal and Eye Research. 2018.
63. Borrelli E, Parravano M, Sacconi R, Costanzo E, Querques L, Vella G, et al. Guidelines on Optical Coherence Tomography Angiography Imaging: 2020 Focused Update. Vol. 9, Ophthalmology and Therapy. 2020.
64. Agemy SA, Scripsema NK, Shah CM, Chui T, Garcia PM, Lee JG, et al. Retinal vascular perfusion density mapping using optical coherence tomography angiography in normals and diabetic retinopathy patients. Retina. 2015;35(11).
65. Takase N, Nozaki M, Kato A, Ozeki H, Yoshida M, Ogura Y. Enlargement of foveal avascular zone in diabetic eyes evaluated by en face optical coherence tomography angiography. Retina. 2015;35(11).
66. Ishibazawa A, Nagaoka T, Takahashi A, Omae T, Tani T, Sogawa K, et al. Optical coherence tomography angiography in diabetic retinopathy: A prospective pilot study. Am J Ophthalmol. 2015;160(1).
67. Elbendary AM, Abouelkheir HY. Bimodal imaging of proliferative diabetic retinopathy vascular features using swept source optical coherence tomography angiography. Int J Ophthalmol. 2018;11(9).
68. Giuffrè C, Carnevali A, Cicinelli MV, Querques L, Querques G, Bandello F. Optical coherence tomography angiography of venous loops in diabetic retinopathy. Ophthalmic Surg Lasers Imaging Retina. 2017;48(6).
69. Ishibazawa A, Nagaoka T, Yokota H, Takahashi A, Omae T, Song YS, et al. Characteristics of retinal neovascularization in proliferative diabetic retinopathy imaged by optical coherence tomography angiography. Invest Ophthalmol Vis Sci. 2016;57(14).
70. Decker NL, Duffy B V., Boughanem GO, Fukuyama H, Castellanos Canales D, Nesper PL, et al. Macular Perfusion Deficits on OCT Angiography Correlate with Nonperfusion on Ultrawide-field Fluorescein Angiography in Diabetic Retinopathy. Ophthalmol Retina. 2023;7(8).
71. Tombolini B, Borrelli E, Sacconi R, Bandello F, Querques G. Diabetic macular ischemia. Vol. 59, Acta Diabetologica. Springer-Verlag Italia s.r.l.; 2022. p. 751–9.
72. Crincoli E, Sacconi R, Querques L, Querques G. OCT angiography 2023 update: focus on diabetic retinopathy. Vol. 61, Acta Diabetologica. 2024.
73. Ashraf M, Nesper PL, Jampol LM, Yu F, Fawzi AA. Statistical model of optical coherence tomography angiography parameters that correlate with severity of diabetic retinopathy. Invest Ophthalmol Vis Sci. 2018;59(10).
74. Chen S, Moult EM, Zangwill LM, Weinreb RN, Fujimoto JG. Geometric Perfusion Deficits: A Novel OCT Angiography Biomarker for Diabetic Retinopathy Based on Oxygen Diffusion. Am J Ophthalmol. 2021 Feb 1;222:256–70.
75. Borrelli E, Sadda SVR, Uji A, Querques G. Pearls and Pitfalls of Optical Coherence Tomography Angiography Imaging: A Review. Vol. 8, Ophthalmology and Therapy. 2019.
76. Sacconi R, Casaluci M, Borrelli E, Mulinacci G, Lamanna F, Gelormini F, et al. Multimodal imaging assessment of vascular and neurodegenerative retinal alterations in type 1 diabetic patients without fundoscopic signs of diabetic retinopathy. J Clin Med. 2019;8(9).
77. De Carlo TE, Chin AT, Bonini Filho MA, Adhi M, Branchini L, Salz DA, et al. Detection of microvascular changes in eyes of patients with diabetes but not clinical diabetic retinopathy using optical coherence tomography angiography. Retina. 2015;35(11).
78. Tsai ASH, Jordan-Yu JM, Gan ATL, Teo KYC, Tan GSW, Lee SY, et al. Diabetic macular ischemia: Influence of optical coherence tomography angiography parameters on changes in functional outcomes over one year. Invest Ophthalmol Vis Sci. 2021;62(1).
79. Samara WA, Shahlaee A, Adam MK, Khan MA, Chiang A, Maguire JI, et al. Quantification of Diabetic Macular Ischemia Using Optical Coherence Tomography Angiography and Its Relationship with Visual Acuity. Ophthalmology. 2017;124(2).
80. Sun Z, Tang F, Wong R, Lok J, Szeto SKH, Chan JCK, et al. OCT Angiography Metrics Predict Progression of Diabetic Retinopathy and Development of Diabetic Macular Edema: A Prospective Study. Ophthalmology. 2019;126(12).
81. Wang W, Guo X, Chen Y, Xiong K, Gong X, Yuan M, et al. Choriocapillaris perfusion assessed using swept source optical coherence tomographic angiography and the severity of diabetic retinopathy. British Journal of Ophthalmology. 2023;107(6).
82. Khalid H, Schwartz R, Nicholson L, Huemer J, El-Bradey MH, Sim DA, et al. Widefield optical coherence tomography angiography for early detection and objective evaluation of proliferative diabetic retinopathy. British Journal of Ophthalmology. 2021;105(1).
83. Cui Y, Zhu Y, Wang JC, Lu Y, Zeng R, Katz R, et al. Comparison of widefield swept-source optical coherence tomography angiography with ultra-widefield colour fundus photography and fluorescein angiography for detection of lesions in diabetic retinopathy. British Journal of Ophthalmology. 2021;105(4).
84. Lu dward S, Cui Y, Le R, Zhu Y, Wang JC, Laíns I, et al. Detection of neovascularisation in the vitreoretinal interface slab using widefield swept-source optical coherence tomography angiography in diabetic retinopathy. British Journal of Ophthalmology. 2022;106(4).
85. Hirano T, Hoshiyama K, Takahashi Y, Murata T. Wide-field swept-source OCT angiography (23 × 20 mm) for detecting retinal neovascularization in eyes with proliferative diabetic retinopathy. Graefe’s Archive for Clinical and Experimental Ophthalmology. 2023;261(2).
86. Li M, Mao M, Wei D, Liu M, Liu X, Leng H, et al. Different scan areas affect the detection rates of diabetic retinopathy lesions by high-speed ultra-widefield swept-source optical coherence tomography angiography. Front Endocrinol (Lausanne). 2023;14.
87. Shah PN, Mishra DK, Falahat P, Fischer L, Guzman G, Terheyden JH, et al. Inter-Rater Reliability of Proliferative Diabetic Retinopathy Assessment on Wide-Field OCT-Angiography and Fluorescein Angiography. Transl Vis Sci Technol. 2023;12(7).
88. Bajka A, Bacci T, Wiest MRJ, Brinkmann M, Hamann T, Toro M, et al. Feasibility and Clinical Utility of Wide-Field Optical Coherence Tomography Angiography Compared to Ultrawide-Field Fluorescein Angiography in Patients with Diabetic Retinopathy. Klin Monbl Augenheilkd. 2022;240(4).
89. Couturier A, Rey PA, Erginay A, Lavia C, Bonnin S, Dupas B, et al. Widefield OCT-Angiography and Fluorescein Angiography Assessments of Nonperfusion in Diabetic Retinopathy and Edema Treated with Anti–Vascular Endothelial Growth Factor. Ophthalmology. 2019;126(12).
90. Russell JF, Al-khersan H, Shi Y, Scott NL, Hinkle JW, Fan KC, et al. Retinal Nonperfusion in Proliferative Diabetic Retinopathy Before and After Panretinal Photocoagulation Assessed by Widefield OCT Angiography. Am J Ophthalmol. 2020;213.
91. Tsuboi K, Mazloumi M, Guo Y, Wang J, Flaxel CJ, Bailey ST, et al. Utility of En Face OCT for the Detection of Clinically Unsuspected Retinal Neovascularization in Patients with Diabetic Retinopathy. Ophthalmol Retina. 2023;7(8).
92. Menean M, Sacconi R, Tombolini B, Fantaguzzi F, Bandello F, Querques G. Combined wide-field imaging in grading diabetic retinopathy. Eye (Basingstoke). 2024;38(1).
93. Zeng Y, Liu M, Li M, Wei D, Mao M, Liu X, et al. Early changes to retinal structure in patients with diabetic retinopathy as determined by ultrawide swept-source optical coherence tomography-angiography. Front Endocrinol (Lausanne). 2023;14.
94. Zhao Q, Wang C, Meng L, Cheng S, Gu X, Chen Y, et al. Central and peripheral changes in the retina and choroid in patients with diabetes mellitus without clinical diabetic retinopathy assessed by ultra-wide-field optical coherence tomography angiography. Front Public Health. 2023;11.
95. Qi Z, Si Y, Feng F, Zhu J, Yang X, Wang W, et al. Analysis of retinal and choroidal characteristics in patients with early diabetic retinopathy using WSS-OCTA. Front Endocrinol (Lausanne). 2023;14.
96. Le R, Cui Y, Lu ES, Zhu Y, Garg I, Wang JC, et al. Prevalence of venous loops and association with retinal ischemia in diabetic retinopathy using widefield swept-source OCT angiography. Graefe’s Archive for Clinical and Experimental Ophthalmology. 2023;261(7).
97. Russell JF, Han IC. Toward a New Staging System for Diabetic Retinopathy Using Wide Field Swept-Source Optical Coherence Tomography Angiography. Vol. 21, Current Diabetes Reports. 2021.
98. Tombolini B, Crincoli E, Sacconi R, Battista M, Fantaguzzi F, Servillo A, et al. Optical Coherence Tomography Angiography: A 2023 Focused Update on Age-Related Macular Degeneration. Vol. 13, Ophthalmology and Therapy. 2024.
99. Gulshan V, Peng L, Coram M, Stumpe MC, Wu D, Narayanaswamy A, et al. Development and validation of a deep learning algorithm for detection of diabetic retinopathy in retinal fundus photographs. JAMA - Journal of the American Medical Association. 2016;316(22).
100. Ting DSW, Cheung CYL, Lim G, Tan GSW, Quang ND, Gan A, et al. Development and validation of a deep learning system for diabetic retinopathy and related eye diseases using retinal images from multiethnic populations with diabetes. JAMAJournal of the American Medical Association. 2017;318(22).
101. Tang F, Luenam P, Ran AR, Quadeer AA, Raman R, Sen P, et al. Detection of Diabetic Retinopathy from Ultra-Widefield Scanning Laser Ophthalmoscope Images: A Multicenter Deep Learning Analysis. Ophthalmol Retina. 2021;5(11).
102. Ryu G, Lee K, Park D, Park SH, Sagong M. A deep learning model for identifying diabetic retinopathy using optical coherence tomography angiography. Sci Rep. 2021;11(1).
103. Abràmoff MD, Lavin PT, Birch M, Shah N, Folk JC. Pivotal trial of an autonomous AI-based diagnostic system for detection of diabetic retinopathy in primary care offices. NPJ Digit Med. 2018;1(1).
104. Heydon P, Egan C, Bolter L, Chambers R, Anderson J, Aldington S, et al. Prospective evaluation of an artificial intelligence-enabled algorithm for automated diabetic retinopathy screening of 30 000 patients. Vol. 105, British Journal of Ophthalmology. 2021.
105. Ipp E, Liljenquist D, Bode B, Shah VN, Silverstein S, Regillo CD, et al. Pivotal Evaluation of an Artificial Intelligence System for Autonomous Detection of Referrable and Vision-Threatening Diabetic Retinopathy. JAMA Netw Open. 2021;4(11).
106. Horton MB, Brady CJ, Cavallerano J, Abramoff M, Barker G, Chiang MF, et al. Practice Guidelines for Ocular Telehealth-Diabetic Retinopathy, Third Edition. Telemed J E Health. 2020;26(4).
107. Silva PS, Horton MB, Clary D, Lewis DG, Sun JK, Cavallerano JD, et al. Identification of Diabetic Retinopathy and Ungradable Image Rate with Ultrawide Field Imaging in a National Teleophthalmology Program. Ophthalmology. 2016;123(6).
108. Rajalakshmi R, Arulmalar S, Usha M, Prathiba V, Kareemuddin KS, Anjana RM, et al. Validation of smartphone based retinal photography for diabetic retinopathy screening. PLoS One. 2015;10(9).
109. Natarajan S, Jain A, Krishnan R, Rogye A, Sivaprasad S. Diagnostic Accuracy of Community-Based Diabetic Retinopathy Screening with an Offline Artificial Intelligence System on a Smartphone. JAMA Ophthalmol. 2019;137(10).
110. Rajalakshmi R, Prathiba V, Arulmalar S, Usha M. Review of retinal cameras for global coverage of diabetic retinopathy screening. Vol. 35, Eye (Basingstoke). 2021.
111. Williams GA, Scott IU, Haller JA, Maguire AM, Marcus D, McDonald HR. Single-field fundus photography for diabetic retinopathy screening: A report by the American Academy of Ophthalmology. Vol. 111, Ophthalmology. 2004.
112. Keenan TDL, Goldstein M, Goldenberg D, Zur D, Shulman S, Loewenstein A. Prospective, Longitudinal Pilot Study: Daily Self-Imaging with Patient-Operated Home OCT in Neovascular Age-Related Macular Degeneration. Ophthalmology Science. 2021;1(2).
113. Maloca P, Hasler PW, Barthelmes D, Arnold P, Matthias M, Scholl HPN, et al. Safety and feasibility of a novel sparse optical coherence tomography device for patient-delivered retina home monitoring. Transl Vis Sci Technol. 2018;7(4).
114. Gross N, Bachmann LM, Islam M, Faes L, Schmid MK, Thiel MA, et al. Visual outcomes and treatment adherence of patients with macular pathology using a mobile hyperacuity home-monitoring app: A matched-pair analysis. BMJ Open. 2021;11(12).
115. Mecklai K, Smith N, Stern AD, Kramer DB. Remote Patient Monitoring — Overdue or Overused? New England Journal of Medicine. 2021;384(15).
116. Crasto W, Patel V, Davies MJ, Khunti K. Prevention of Microvascular Complications of Diabetes. Endocrinol Metab Clin North Am. 2021 Sep 1;50(3):431–55.
117. Wong TY, Sun J, Kawasaki R, Ruamviboonsuk P, Gupta N, Lansingh VC, et al. Guidelines on Diabetic Eye Care: The International Council of Ophthalmology Recommendations for Screening, Follow-up, Referral, and Treatment Based on Resource Settings. Vol. 125, Ophthalmology. 2018.
118. Vujosevic S, Benetti E, Massignan F, Pilotto E, Varano M, Cavarzeran F, et al. Screening for Diabetic Retinopathy: 1 and 3 Nonmydriatic 45-degree Digital Fundus Photographs vs 7 Standard Early Treatment Diabetic Retinopathy Study Fields. Am J Ophthalmol. 2009;148(1).
119. Scanlon PH, Malhotra R, Greenwood RH, Aldington SJ, Foy C, Flatman M, et al. Comparison of two reference standards in
validating two field mydriatic digital photography as a method of screening for diabetic retinopathy. British Journal of Ophthalmology. 2003;87(10).
120. Early Photocoagulation for Diabetic Retinopathy: ETDRS Report Number 9. Ophthalmology. 1991;98(5).
121. Bandello F, Polito A, Del Borrello M, Zemella N, Isola M. “Light” versus “classic” laser treatment for clinically significant diabetic macular oedema. British Journal of Ophthalmology. 2005;89(7).
122. Chhablani J, Mathai A, Rani P, Gupta V, Fernando Arevalo J, Kozak I. Comparison of conventional pattern and novel navigated panretinal photocoagulation in proliferative diabetic retinopathy. Invest Ophthalmol Vis Sci. 2014;55(6).
123. Chappelow A V., Tan K, Waheed NK, Kaiser PK. Panretinal photocoagulation for proliferative diabetic retinopathy: Pattern scan laser versus argon laser. Am J Ophthalmol. 2012;153(1).
124. Techniques for scatter and local photocoagulation treatment of diabetic retinopathy: Early Treatment Diabetic Retinopathy Study Report no. 3. The Early Treatment Diabetic Retinopathy Study Research Group. Int Ophthalmol Clin. 1987;27(4).
125. Fong DS, Girach A, Boney A. Visual side effects of successful scatter laser photocoagulation surgery for proliferative diabetic retinopathy: A literature review. Vol. 27, Retina. 2007.
126. Wells JA, Glassman AR, Ayala AR, Jampol LM, Aiello LP, Antoszyk AN. Diabetic Retinopathy Clinical Research Network. Aflibercept, bevacizumab, or ranibizumab for diabetic macular edema. N Engl J Med. 2015;372(13).
127. Tadayoni R, Sararols L, Weissgerber G, Verma R, Clemens A, Holz FG. Brolucizumab: A Newly Developed Anti-VEGF Molecule for the Treatment of Neovascular Age-Related Macular Degeneration. Vol. 244, Ophthalmologica. 2021.
128. Sahni J, Patel SS, Dugel PU, Khanani AM, Jhaveri CD, Wykoff CC, et al. Simultaneous Inhibition of Angiopoietin-2 and Vascular Endothelial Growth Factor-A with Faricimab in Diabetic Macular Edema: BOULEVARD Phase 2 Randomized Trial. Ophthalmology. 2019;126(8).
129. Khanani AM, Patel SS, Ferrone PJ, Osborne A, Sahni J, Grzeschik S, et al. Efficacy of Every Four Monthly and Quarterly Dosing of Faricimab vs Ranibizumab in Neovascular Age-Related Macular Degeneration: The STAIRWAY Phase 2 Randomized Clinical Trial. In: JAMA Ophthalmology. 2020.
130. Edelman JL. Differentiating intraocular glucocorticoids. Vol. 224, Ophthalmologica. 2010.
131. Antonetti DA, Wolpert EB, DeMaio L, Harhaj NS, Scaduto RC. Hydrocortisone decreases retinal endothelial cell water and solute flux coincident with increased content and decreased phosphorylation of occludin. J Neurochem. 2002;80(4).
132. Bhisitkul RB, Winn BJ, Lee OT, Wong J, Pereira DDS, Porco TC, et al. Neuroprotective effect of intravitreal triamcinolone acetonide against photoreceptor apoptosis in a rabbit model of subretinal hemorrhage. Invest Ophthalmol Vis Sci. 2008;49(9).
133. Photocoagulation For Diabetic Macular Edema: Early Treatment Diabetic Retinopathy Study Report Number 1 Early Treatment Diabetic Retinopathy Study Research Group. Archives of Ophthalmology. 1985;103(12).
134. Mitchell P, Bandello F, Schmidt-Erfurth U, Lang GE, Massin P, Schlingemann RO, et al. The RESTORE study: Ranibizumab monotherapy or combined with laser versus laser monotherapy for diabetic macular edema. Ophthalmology. 2011;118(4).
135. Elman MJ, Qin H, Aiello LP, Beck RW, Bressler NM, Ferris FL, et al. Intravitreal ranibizumab for diabetic macular edema with prompt versus deferred laser treatment: Three-year randomized trial results. Ophthalmology. 2012;119(11).
136. Do D V., Nguyen QD, Khwaja AA, Channa R, Sepah YJ, Sophie R, et al. Ranibizumab for edema of the macula in diabetes study: 3-year outcomes and the need for prolonged frequent treatment. JAMA Ophthalmol. 2013;131(2).
137. Focal Photocoagulation Treatment of Diabetic Macular Edema: Relationship of Treatment Effect to Fluorescein Angiographic and Other Retinal Characteristics at Baseline: ETDRS Report No. 19. Archives of Ophthalmology. 1995;113(9).
138. Nguyen QD, Brown DM, Marcus DM, Boyer DS, Patel S, Feiner L, et al. Ranibizumab for diabetic macular edema: Results from 2 phase iii randomized trials: RISE and RIDE. Ophthalmology. 2012;119(4).
139. Mitchell P, Bandello F, Schmidt-Erfurth U, Lang GE, Massin P, Schlingemann RO, et al. Expanded {2-Year} Follow-up of Ranibizumab Plus Prompt or Deferred Laser or Triamcinolone Plus Prompt Laser for Diabetic Macular Edema. Ophthalmology. 2011;118(4).
140. Do D V., Nguyen QD, Boyer D, Schmidt-Erfurth U, Brown DM, Vitti R, et al. One-year outcomes of the da VINCI study of VEGF trap-eye in eyes with diabetic macular edema. In: Ophthalmology. 2012.
141. Elman MJ, Aiello LP, Beck RW, Bressler NM, Bressler SB, Edwards AR, et al. Randomized Trial Evaluating Ranibizumab Plus Prompt or Deferred Laser or Triamcinolone Plus Prompt Laser for Diabetic Macular Edema. Ophthalmology. 2010;117(6).
142. Brown DM, Nguyen QD, Marcus DM, Boyer DS, Patel S, Feiner L, et al. Long-term outcomes of ranibizumab therapy for diabetic macular edema: The 36-month results from two phase III trials: RISE and RIDE. Ophthalmology. 2013;120(10).
143. Payne JF, Wykoff CC, Clark WL, Bruce BB, Boyer DS, Brown DM, et al. Randomized Trial of Treat and Extend Ranibizumab With and Without Navigated Laser Versus Monthly Dosing for Diabetic Macular Edema: TREX-DME 2-Year Outcomes. Am J Ophthalmol. 2019;202.
144. Kilpatrick ES, Rigby AS, Atkin SL, Frier BM. Does severe hypoglycaemia influence microvascular complications in Type1 diabetes? An analysis of the Diabetes Control and Complications Trial database. Diabetic Medicine. 2012;29(9).
145. Brown DM, Boyer DS, Do D V., Wykoff CC, Sakamoto T, Win P, et al. Intravitreal aflibercept 8 mg in diabetic macular oedema (PHOTON): 48-week results from a randomised, double-masked, non-inferiority, phase 2/3 trial. The Lancet. 2024;403(10432).
146. Bressler NM, Beaulieu WT, Maguire MG, Glassman AR, Blinder KJ, Bressler SB, et al. Early Response to Anti–Vascular Endothelial Growth Factor and Two-Year Outcomes Among Eyes With Diabetic Macular Edema in Protocol T . Am J Ophthalmol. 2018;195.
147. Sorour OA, Levine ES, Baumal CR, Elnahry AG, Braun P, Girgis J, et al. Persistent diabetic macular edema: Definition, incidence, biomarkers, and treatment methods. Vol. 68, Survey of Ophthalmology. 2023.
148. Sivaprasad S, Crosby-Nwaobi R, Heng LZ, Peto T, Michaelides M, Hykin P. Injection frequency and response to bevacizumab monotherapy for diabetic macular oedema (BOLT Report 5). British Journal of Ophthalmology. 2013;97(9).
149. Busch C, Zur D, Fraser-Bell S, Laíns I, Santos AR, Lupidi M, et al. Shall we stay, or shall we switch? Continued anti-VEGF therapy versus early switch to dexamethasone implant in refractory diabetic macular edema. Acta Diabetol. 2018;55(8).
150. Bruè C, Pazzaglia A, Mariotti C, Reibaldi M, Giovannini A. Aflibercept as primary treatment for myopic choroidal neovascularisation: A retrospective study. Eye (Basingstoke). 2016;30(1).
151. Brown DM, Emanuelli A, Bandello F, Barranco JJE, Figueira J, Souied E, et al. KESTREL and KITE: 52-Week Results From Two Phase III Pivotal Trials of Brolucizumab for Diabetic Macular Edema. Am J Ophthalmol. 2022;238.
152. Wykoff CC, Garweg JG, Regillo C, Souied E, Wolf S, Dhoot DS, et al. KESTREL and KITE Phase 3 Studies: 100-Week Results With Brolucizumab in Patients With Diabetic Macular Edema. Am J Ophthalmol. 2024 Apr 1;260:70–83.
153. Witkin AJ, Hahn P, Murray TG, Arevalo JF, Blinder KJ, Choudhry N, et al. Occlusive Retinal Vasculitis Following Intravitreal Brolucizumab. J Vitreoretin Dis. 2020;4(4).
154. Garweg JG. A Randomized, Double-Masked, Multicenter, Phase III Study Assessing the Efficacy and Safety of Brolucizumab versus Aflibercept in Patients with Visual Impairment due to Diabetic Macular Edema (KITE). Klin Monbl Augenheilkd. 2020;237(4).
155. Wykoff CC, Abreu F, Adamis AP, Basu K, Eichenbaum DA, Haskova Z, et al. Efficacy, durability, and safety of intravitreal faricimab with extended dosing up to every 16 weeks in patients with diabetic macular oedema (YOSEMITE and RHINE): two randomised, double-masked, phase 3 trials. The Lancet. 2022;399(10326).
156. Wong TY, Haskova Z, Asik K, Baumal CR, Csaky KG, Eter N, et al. Faricimab Treat-and-Extend for Diabetic Macular Edema: Two-Year Results from the Randomized Phase 3 YOSEMITE and RHINE Trials. Ophthalmology. 2024;131(6).
157. Panos GD, Lakshmanan A, Dadoukis P, Ripa M, Motta L, Amoaku WM. Faricimab: Transforming the Future of Macular Diseases Treatment-A Comprehensive Review of Clinical Studies. Vol. 17, Drug Design, Development and Therapy. 2023.
158. Fong DS, Strauber SF, Aiello LP, Beck RW, Callanan DG, Danis RP, et al. Comparison of the modified early treatment diabetic retinopathy study and mild macular grid laser photocoagulation strategies for diabetic macular edema. Archives of Ophthalmology. 2007;125(4).
159. Jorge EC, Jorge EN, Botelho M, Farat JG, Virgili G, El Dib R. Monotherapy laser photocoagulation for diabetic macular oedema. Vol. 2018, Cochrane Database of Systematic Reviews. 2018.
160. Wu Y, Ai P, Ai Z, Xu G. Subthreshold diode micropulse laser versus conventional laser photocoagulation monotherapy or combined with anti-VEGF therapy for diabetic macular edema: A Bayesian network meta-analysis. Vol. 97, Biomedicine and Pharmacotherapy. 2018.
161. Campochiaro PA, Brown DM, Pearson A, Ciulla T, Boyer D, Holz FG, et al. Long-term benefit of sustained-delivery fluocinolone acetonide vitreous inserts for diabetic macular edema. Ophthalmology. 2011;118(4).
162. Mehta H, Fraser-Bell S, Campain A, Gillies MC. Anti-vascular endothelial growth factor combined with intravitreal steroids for diabetic macular oedema. Cochrane Database of Systematic Reviews. 2015;2015(3).
163. Vitrectomy Outcomes in Eyes with Diabetic Macular Edema and Vitreomacular Traction. Ophthalmology. 2010;117(6).
164. Klein R, Klein BEK, Moss SE, Davis MD, Demets DL. The Wisconsin Epidemiologic Study of Diabetic Retinopathy: Ix. Four-Year Incidence and Progression of Diabetic Retinopathy when Age at Diagnosis is Less than 30 Years. Archives of Ophthalmology. 1989;107(2).
165. Ferris F. Early photocoagulation in patients with either type I or type II diabetes. In: Transactions of the American Ophthalmological Society. 1996.
166. Sivaprasad S, Prevost AT, Vasconcelos JC, Riddell A, Murphy C, Kelly J, et al. Clinical efficacy of intravitreal aflibercept versus panretinal photocoagulation for best corrected visual acuity in patients with proliferative diabetic retinopathy at 52 weeks (CLARITY): a multicentre, single-blinded, randomised, controlled, phase 2b, non-inferiority trial. The Lancet. 2017;389(10085).
167. Gross JG, Glassman AR, Jampol LM, Inusah S, Aiello LP, Antoszyk AN, et al. Panretinal photocoagulation vs intravitreous ranibizumab for proliferative diabetic retinopathy: A randomized clinical trial. JAMA - Journal of the American Medical Association. 2015;314(20).
168. Bressler SB, Liu D, Glassman AR, Blodi BA, Castellarin AA, Jampol LM, et al. Change in diabetic retinopathy through 2 years secondary analysis of a randomized clinical trial comparing aflibercept, bevacizumab, and ranibizumab. JAMA Ophthalmol. 2017;135(6).
169. Early Vitrectomy for Severe Proliferative Diabetic Retinopathy in Eyes with Useful Vision: Results of a Randomized Trial—Diabetic Retinopathy Vitrectomy Study Report 3. Ophthalmology. 1988;95(10).
170. Smith JM, Steel DHW. Anti-vascular endothelial growth factor for prevention of postoperative vitreous cavity haemorrhage after vitrectomy for proliferative diabetic retinopathy. Vol. 2015, Cochrane Database of Systematic Reviews. 2015.
171. Wang JH, Roberts GE, Liu GS. Updates on Gene Therapy for Diabetic Retinopathy. Vol. 20, Current Diabetes Reports. 2020.
172. Shughoury A, Bhatwadekar A, Jusufbegovic D, Hajrasouliha A, Ciulla TA. The evolving therapeutic landscape of diabetic retinopathy. Vol. 23, Expert Opinion on Biological Therapy. 2023.
Edoardo Midena, Luisa Frizziero
Retinal vascular diseases are often closely linked with cardiovascular and other systemic diseases. These associations are significant because retinal vasculature can reflect the state of the systemic circulation, making it a useful window for the diagnosis and monitoring of various conditions. Regular retinal examinations can help detect these associations early, allowing timely management of both ocular and systemic diseases. Managing systemic conditions such as diabetes, hypertension, and hyperlipidemia is crucial to prevent or mitigate the progression of retinal vascular diseases.
Two major categories of vascular occlusive diseases involve the retina: vein and artery occlusions.
Even if the pathophysiology and systemic implications of the two forms of occlusions differ greatly: both cases are strictly related to the systemic vascular condition of the patient and require a specific systemic evaluation. Most frequent underlying conditions are diabetes, hypertension, hypercholesterolemia, smoking, glaucoma, and atherosclerosis.[1]
Central (CRAO) or branch retinal artery occlusion (BRAO) is defined as the interruption of blood flow through the central or a branch retinal artery by thromboembolism or vasospasm with or without retinal ischemia. [2] CRAO refers to a compromise of blood flow via the central retinal artery to the inner layers of the retina, most frequently due to the presence of emboli. This may result in a retinal infarction, and when it occurs, the diagnosis of acute ischemic stroke is confirmed.
The age- and sex-adjusted incidence of CRAO ranges between 1.8 and 2.5 per 100 000 person-years in different countries rising to 26-93/100 000 person-years in people >80 years of age.[2–4]
The incidence of asymptomatic branch retinal arterial emboli is far higher, with a cumulative 10-year incidence of 2.9% in ≥49 years people, while the incidence of symptomatic occlusion of branch retinal arteries is about 30% that of CRAO.[2] CRAO significantly affects patients’ quality of life and increases the likelihood of subsequent cardio-cerebrovascular events[4]
The most common cause of acute disruption of the retinal blood supply is the presence of emboli. This is most strongly associated with an ipsilateral internal carotid artery stenosis, but emboli can also arise from the heart (including the aortic and mitral valves), aortic arch, or great vessels.[2,5,6] 10.5% of these emboli have been reported to be made of calcific material, 15.5% of fibrin, and 74% of cholesterol.[7]
The most important determinant of retinal damage and final visual outcome is the duration
of occlusion of the central retinal artery. Studies on elderly, atherosclerotic, and hypertensive rhesus monkeys showed no detectable optic nerve or retinal damage secondary to CRAO if it was present for <97 minutes, whereas after 240 minutes of occlusion, severe and irreversible damage occurred.[8,9]
A cilioretinal artery may originate from the posterior ciliary circulation, not the central retinal arterial circulation. It is present in 20-25% of the population and it perfuses the macula. Therefore, even in acute cases of CRAO, a cilioretinal artery may maintain a good vision in patients with CRAO, depending on the variable size of the cilioretinal artery and the region it supplies. Regardless, peripheral vision would still be impaired.[2,7]
Most cases (95%) of CRAO are classified as nonarteritic, whereas in 5% of cases CRAO are defined as arteritic, being part of an inflammatory disorder. The most common cause of arteritic CRAO is giant cell arteritis (GCA), an idiopathic vasculitis that mostly affects the upper body and head in older persons, resulting in small- to medium-sized artery stenosis and occlusion. Eyes with GCA-induced CRAO frequently have coexistent arteritic anterior ischemic optic neuropathy (AION) and choroidal ischemia resulting from the vasculitic occlusion of the posterior ciliary arteries. The prognosis is worse in people with arteritic CRAO.[2,7] CRAO may also be secondary to infectious and inflammatory systemic diseases, including other autoimmune vasculitides. Iatrogenic case of CRAO have been also reported as a complication of cosmetic facial injections.[2]
The diagnosis of CRAO is made by identifying classic clinical findings of sudden, painless vision loss, relative afferent pupillary defect, and funduscopic signs of retinal hypoperfusion. [2,10] The typical funduscopic findings include retinal edema (evident as retinal whitening), a cherry-red spot (as a result of preserved choroidal circulation underlying the fovea that is surrounded by pale, ischemic retina), slow segmental blood flow (known as boxcarring) in the retinal arteries that are attenuated and constricted, and usually a normal-appearing optic disc.[2,7] The association of optic disc edema with acute CRAO indicates the rare combination of AION and inner retinal ischemia, likely reflecting a vasculitis affecting the posterior ciliary arteries as well [2,11]. Sometimes emboli may be seen in the retinal vasculature. Their morphology may be useful in establishing the etiology of CRAO. Yellow, refractile plaques, also known as “Hollenhorst plaques”, may indicate cholesterol emboli, while small, pale bodies are indicators of fibrin-platelet emboli, and single, white, non-scintillating plaques of calcific emboli in the proximal retinal vasculature.[7]
Early in the occlusive event, the fundus may appear relatively normal; however, history of sudden painless vision loss and the presence of a relative afferent pupil defect, an attached retina, and normal optic nerve should be quite suspicious. Imaging modalities such as optical coherence tomography (OCT), optical coherence tomography angiography (OCTA), or fluorescein angiography (FA) can support the diagnosis of CRAO; particularly, optical coherence tomography can detect inner retinal edema easily, non-invasively and fastly, also in the acute setting. Relative retinal thickness increase at OCT may help in identifying the time onset of ischemia in CRAO, as well as identify patients that are potentially eligible for a beneficial reperfusion therapy which is limited by a strict a therapeutic window.[12]
FA can show delayed or absent retinal perfusion and retinal arterial branch occlusions but require dye and it is time-consuming and usually not necessary to establish a definite diagnosis.[2,13]
Regarding the natural history of CRAO, the visual prognosis is usually poor with a final “counting fingers” or worse visual acuity. Only 22% of patients show any improvement within a week
of onset. [4,7]
Smaller emboli may migrate in retinal arterial branches and result in BRAO, which has a better visual prognosis than CRAO. These patients complain of acute partial monocular visual loss, often described as a superior or inferior shade, and visual acuity varies greatly, depending on anatomic variations of retinal vascularization.[1] The morphologic features reported for CRAO also identify BRAO, but involving partial retinal regions and the patients’ management is the same.
Once diagnosis of RAO is established or strongly suspected, immediate triage to an emergency department is necessary and should not be delayed, since a high rate of serious comorbidities exists, including stroke or acute myocardial infarction. [2,4] Asymptomatic, multiple, small cerebral infarctions have also been reported using brain magnetic resonance imaging within 15 days of visual loss for acute retinal artery occlusions. [1] Assessment of the atherosclerotic risk factors is recommended, including diabetes, hyperlipidemia, family history of cerebrovascular and cardiovascular disease, atherosclerotic cardiac or cerebrovascular disease, valvular heart disease, and transient ischemic events, such as transient monocular blindness, or angina symptoms. A physical exam of the cardiovascular system should be the major focus to evaluate vascular risk and identify possible causes. Basic evaluation should include high blood pressure and diabetes testing for all patients, sedimentation rate, carotid Doppler and cardiac sonogram should always be obtained for retinal arterial disease. When no atherosclerotic risk factors are identified, additional causes should be investigated, particularly in young patients. These include, autoimmune connective tissue diseases, the usage of ocular or intravenous medications, myeloproliferative illnesses, vasculitis, sickle cell disease, and hypercoagulable conditions.[7]
In the acute phase, ocular perfusion restoration should be attempted. However, despite being comparable to the severity of brain stroke, there is no accepted course of treatment or model of care. Currently, “standard” therapies are still used, including methylprednisolone, intravenous acetazolamide, mannitol, systemic pentoxifylline, sublingual isosorbide dinitrate, oxygen therapy, anterior chamber paracentesis, globe compression, and ocular massage. [7,14] The rationale is improving retinal perfusion by lowering the intraocular pressure, increasing vasodilation, facilitating adequate oxygen diffusion.[4] The success rate of this type of therapy ranges from 6% to 49%, however with limited results in terms of visual acuity. [7]
Intravenous tissue plasminogen activator (tPA) is an evidence-based therapy for acute ischemic stroke. To date, there have been no adequate randomized clinical trials of intravenous tPA in retinal artery occlusion because previous attempts were limited as a result of difficulty with patient enrollment. An updated meta-analysis demonstrated a strong effect with treatment within 4.5 hours.[15]
Cerebral hemorrhage is the main side effect of thrombolysis.[7] At present the decision to use intravenous tPA and/or other treatments derives from a thorough discussion between the treating specialist and the affected patient, which includes an acknowledgment of the limitations inherent in the literature to date.[2]
There is also no agreement on the optimum post-CRAO follow-up strategy for identifying ocular neovascular issues. Normal neovascularization starts eight weeks (2-16 weeks) following CRAO. Therefore, it is prudent to conduct routine examinations after CRAO.[7]
In case of arteritic CRAO, superficial temporal artery biopsy is important for the diagnosis of GCA. It usually shows concentric intimal hyperplasia, disruption of the internal elastic lamina, and infiltration of multinucleated giant cells; however, the absence of giant cells on biopsy does not exclude the possibility of GCA. Diagnosis can be also confirmed by an elevated
C-reactive protein level, increased erythrocyte sedimentation rate and the presence of fever, systemic headache, otalgia, and chewing pain. High-dose corticosteroids are administered but, since the ophthalmic artery is involved, both the central retinal artery and ciliary arteries are blocked, hindering improvements in visual acuity.[4]
In 15-17% of patients, CRAO may be “transient”, leading to better visual prognosis. It has been linked to transient vasospasm brought on by platelets’ release of serotonin on atherosclerotic plaques, emboli migration, sudden drop in intraocular pressure or increase in perfusion pressure. It is analogous to an ophthalmic transient ischemic attack, and the duration of CRAO may range from a few minutes to hours, subject to the source of obstruction. The degree to which the visual acuity will depend on how long the transient CRAO lasts. However the same systemic management of non transient CRAO is required. [7]
In the spectrum of the disease also ophthalmic artery occlusion (usually by a large embolus or thrombus) is included. It variably involves infarction of the inner and outer retina, optic nerve head, globe, and ocular tissues, also depending on the degree of collateral flow from the external carotid artery circulation. The prognosis is poor, with vision reduced to hand motion or worse, and most affected eyes develop ischemic neovascularization with numerous ocular complications.[1]
Retinal vein occlusions
Retinal vein occlusions (RVOs) are much more common than retinal arterial occlusions, being the most frequent primary vascular disorder of the retina, second only to diabetic retinopathy. The first description of a case with central retinal vein occlusion dates from 1855 but only in 1878 von Michel defined the findings as central vein thrombosis.[16,17] The incidence of RVOs ranges between 0.03-0.08% and 0.1-0.4% for central (CRVO) and branch RVO (BRVO), respectively. The mean age of patients is between 60 and 70 years. About 10% are younger than 50 years. Five to 11% of patients will suffer from CRVO in their other eye within 5 years. [1,18,19] CRVO and BRVO are the consequence of thrombosis within the central retinal vein or within a branch retinal vein, respectively. Diabetes mellitus, arterial hypertension, cardiovascular disease, obesity, hyperlipidemia, hyperhomocysteinemia, smoking, glaucoma and trauma are significant risk factors. Systemic vascular comorbidities can compromise endothelial cells, facilitating the development of thrombi, where venous lumen normally narrows and blood flow increases. This usually happens for the central retinal vein at the level of the lamina cribrosa, leading to CRVO. BRVOs occur at arteriovenous crossing sites, mainly those in which the artery passes over the vein. Hemodynamic disturbances leading to stagnation and primary thrombus formation and degenerative and/or inflammatory disease within the vein may contribute to the development. Hyperviscosity and thrombophilia seem also to facilitate RVOs. Vitreous attachment at the macula or at arteriovenous crossings may play an important pathogenetic role. The extent of the blood-retinal barrier breakdown and ischemia define the course of the retinopathy. Triggering mostly happens at nighttime in the recumbent position probably by low blood pressure, and/or high central venous pressure.
CRVO and BRVO usually present as acute painless blurred vision in one eye. The morphological features of RVO may vary among patients. However retinal venous dilation or tortuosity with diffuse retinal flame and dot blot hemorrhages are pathognomonic characteristics, within a spectrum from mild to severe. (Figure 1, 2)
Dilated capillaries and microaneurysms may be found. Moreover, hyperemic swollen optic disc and cotton wool patches caused by infarcts in the nerve fiber layer may be present, frequently associated with retinal non perfusion. Late features include cilioretinal collaterals on the optic disc and macular scar. A range of terms has been used to describe the course


of this disease ranging from very benign to disastrous. Since 1983, the most adequate and widely used designation is non-ischemic or perfused for the milder form of RVO and ischemic or non-perfused for the severe form, as proposed by Hayreh.[20] Eyes with ischemic CRVO frequently present with poor vision, relative afferent pupillary defect, large areas of retinal non-perfusion on FA, and frequently develop iris neovascularization with subsequent neovascular glaucoma. Eyes with non-ischemic CRVO present with better vision, little or no retinal non-perfusion, and leakage from perifoveal capillaries resulting in macular edema.[1]
Particularly when affected by BRVO, patients may be unaware of the unilateral vision loss and delay seeking medical attention. Many patients become aware of the problem because of reduction in depth perception, or, when the unaffected eye is inadvertently obstructed.
The Central Vein Occlusion Study defined eyes with ten or more optic disc areas of retinal non-perfusion measured in seven central photographic fields of FA as ischemic and reported that initially perfused eyes, particularly those with best-corrected visual acuity worse than 20/200, CRVO duration of less than 1 month, or some areas (five to nine optic disc areas) of retinal non-perfusion, developed ten or more optic disc areas of retinal non-perfusion or iris neovascularization (or both) within 4 months, with progressive retinal non-perfusion throughout the 3-year trial in many eyes.[1,21]. However, no consensus exists on the extent or location of macular non-perfusion on FA or OCT angiography that can cause loss of vision. Similarly, no solid consensus exists on the retinal non-perfusion area and risk of neovascularization in BRVO.[19,22] Moreover, even non-ischemic RVO may develop neovascularization.[23]
The SCORE Study Report reports a 36-month incidence of 8.8 and 7.6% of retinal neovascularization in BRVO and CRVO.[22,24] Old age and diabetes mellitus seem to be risk factors for progression to ischemia.[25] Bad perfusion leads to ischemia of inner retina with release of growth factors. Hypoxia-induced vascular endothelial growth factor (VEGF) is most likely the link between retinal ischemia and neovascular disease of the iris and retina in CRVO. VEGF-induced endothelial cell hypertrophy, moreover, may cause further capillary closure in this disease and may exacerbate the ongoing ischemic retinopathy. As a result, Rubeosis iridis can occur and, if left untreated, retinal neovascularization and neovascular glaucoma may ensue. FA is the standard of care for the evaluation of retinal non perfusion. Two new imaging technologies, OCT angiography and ultra-widefield FA (UWF-FA), have been proposed for evaluating non-perfusion. The advantage of the UWF-FA is that it can display a much larger surface of the retina.[22] If hemorrhages preclude reliable evaluation of retinal perfusion on FA, this examination can be postponed as they often disappear allowing the visibility of fundus details. Monitoring of signs of ischemia and neovascularization should continue during follow-up at least by monitoring VA, the iris, and the fundus.[22]
In BRVOs, neovascular glaucoma and severe vision loss are less common than in CRVO, since a less extensive area of the retina is affected. Moreover, rather than iris, retinal neovascularization is more likely to cause damage, and its major vision-threatening complication is vitreous hemorrhage as well as occasionally traction retinal detachment. Macular edema is the most common cause of vision loss.[1] OCT is the gold standard to diagnose and monitor macular edema. Different morphological markers have been studied, including hyperreflective retinal foci, central retinal thickness, the photoreceptor status, the disorganization of inner retinal layers. However, the impact of individual morphologic changes on visual function remains unclear. OCT angiography has been suggested to monitor the retinal microvasculature over time, in addition to regular OCT and FA imaging, when available.[22]
As soon as the diagnosis of retinal vein occlusion is done, medical history and physical examination are important to identify comorbidities and make sure they are optimally controlled, as well as to screen for signs and symptoms that could indicate systemic illness that may be
associated with RVO (e.g. a hypercoagulable state). Laboratory testing is guided by history and physical findings, and if there are non-specific findings, or in patients younger than 40 years or with bilateral of simultaneous CRVOor BRVO, common causes of hypercoagulable states such as Waldenström or multiple myeloma should be ruled out.[1] Lowering of risk factors may inhibit CRVO progression from non ischemic to ischemic, or possibly reduce the frequency of recurrences or involvement of the second eye.
The therapeutic management of RVOs mainly aims to control their complications, namely retinal non perfusion and macular edema. Therapies directed at resolution of the vein occlusion did not show an established proven benefit. Thrombolytics are not indicated in retinal vein occlusion, and administration of anticoagulants is only recommended in patients with a known underlying thrombophilia. Attempts have been made to create anastomoses through surgery and laser, to relieve the obstruction through thrombolytic administration, and to relieve the congestion via optic nerve sheathotomy. Most of the limitations in these strategies result from complications of the intervention performed.[19]
Grid laser photocoagulation was studied in the 80s and 90s to evaluate its effect on macular edema secondary to CRVO and BRVO. The results lead to its establishment as the standard of care for macular edema associated with BRVO, but not for CRVO, where similar results were obtained compared to observation. [19,26,27] Intravitreal therapies have been introduced later. Inflammation plays an important role in the pathogenesis of RVO, promoting vascular permeability contributing to macular edema. However, the use of intravitreal triamcinolone did not report significant advantages when compared to the standard of care for both CRVO and BRVO in The Standard Care vs Corticosteroid for Retinal Vein Occlusion (SCORE).[28] The Global Evaluation of implantable dExamethasone in retinal VEIN occlusion (GENEVA) trial showed that dexamethasone biodegradable implant (Ozurdex®) improves visual acuity, with a peak effect after 2 months and a progressive decline to baseline values at 6 months. Visual acuity improvement can be effectively achieved after a second injection at month 6 (now 4) over a 1-year follow-up.[29,30] The dexamethasone implant was approved by the US Food and Drug Administration (FDA) for RVO-associated macular edema in 2009.[19]
Currently, treatment with anti-VEGF intravitreal injections is among the first line treatments for macular edema secondary to RVOs. The BRAVO and the CRUISE studies explored the use of ranibizumab for macular edema secondary to BRVO and CRVO respectively. They found robust anatomic and visual improvement in the ranibizumab group compared to sham. Open label extension in the HORIZON trial confirmed that the benefit of treatment is generally maintained.[31–34] The GALILEO and COPERNICUS trial showed the efficacy of aflibercept in comparison with sham injection monthly over 1 and 2 years and the VIBRANT study in comparison with grid laser.[35–37]
Moreover, all these studies showed that patients groups who received intravitreal treatment first, obtained better functional results, suggesting that treatment should be provided as soon as reasonable for the patient.[19,39] One of the main disadvantages of intravitreal therapies is that, in most patients with retinal vein occlusion, frequent intravitreal injections are needed for many years, and it is difficult to maintain the visit and injection frequency needed for optimal outcomes.
Regarding retinal non-perfusion and neovascularization, laser photocoagulation is the standard of care for the treatment of neovascular complications associated with RVO, including retinal and disc neovascularization secondary to BRVO or CRVO as well as iris neovascularization [11, 40]. The mechanism of panretinal laser photocoagulation has been attributed to the destruction of ischemic retina, leading to an improved blood supply to the remaining retina and decrease in VEGF production.[22] The central vein occlusion study found that prophylactic pan-
retinal photocoagulation did not prevent the development of iris or angle neovascularization in eyes with extensive capillary non-perfusion. Therefore, panretinal photocoagulation was recommended only after a visible neovascularization, thus requiring a close follow-up. Where this is not possible, prophylactic photocoagulation should be considered as early panretinal photocoagulation (within 90 days of onset of the CRVO) can prevent iris neovascularization in ischemic CRVO. Scatter laser photocoagulation has also shown to be very effective in causing regression of neovascularization.[22,26,40]
Arterial hypertension is one of the strongest risk factors for retinal vascular occlusions.[41] The World Health Organization defines hypertension as a systolic blood pressure greater than 140 mmHg and/or a diastolic blood pressure greater than 90 mmHg, with an estimated 1.13 billion people worldwide affected by this condition.[42] It leads to the development of hypertensive retinopathy, which is an acquired bilateral disease whose classification has been used for monitoring the severity of vascular alterations. In the past, this was the only way to assess the status of systemic microcirculation. Long standing arterial hypertension over a period of months to years leads to organic vascular changes similar or identical to those in arteriosclerosis. Findings in chronic hypertension include not only narrowed caliber of the arterioles but also wide, bright reflexes of the arteries. In this early, vasoconstrictive phase, the local autoregulatory mechanisms come into play. This causes vasospasm and decrease in the arteriole to venule ratio. In older patients with arteriosclerosis, focal arteriolar narrowing develops, as affected vascular segments cannot undergo narrowing. The persistence of hypertension lead to subsequent sclerotic phase characterized by changes in vessel wall, namely thickening of the intima layer, hyperplasia of media layer and hyaline degeneration of the arteriolar wall. Arteriolar narrowing is more evident, associated with arteriovenous crossing changes, and widening and accentuation of light reflex (silver and copper wiring). Arteriovenous crossing changes occur when a thickened arteriole crosses over a venule and compresses it as the vessels share a common adventitious sheath. The vein, in turn, appears dilated and torturous distal to the crossing. In patients with severely increased blood pressure an exudative phase may develop, characterized by the disruption of the blood-brain barrier and leakage of blood and plasma into the vessel wall disrupting the autoregulatory mechanisms. In this stage, retinal hemorrhage (flame-shaped and dot blot), hard exudate, cotton-wool spots and retinal ischemia may be identified. Optic disk swelling (hypertensive optic neuropathy) and retinal edema may be identified, eventually associated with serous retinal detachment.[43]
Different clinical stages of the disease have been proposed according to the retinal features identified, but the classification is not extensively used for the clinical management of hypertensive retinopathy, even if the identification of early and late signs may be important for the systemic management of the disease.[44]
Signs of choroidopathy may be associated to the above mentioned features, including Elschnig’s spots, appearing as yellow alteration of the retinal pigment epithelium, Siegrist’s streak, due to retinal pigment epithelium hyperplasia over choroidal infarcts and neurosensory retinal pigment epithelium detachments.[44] Hypertensive choroidopathy is due to fibrinoid necrosis of choroidal arterioles, with resultant non-perfusion of the overlying choriocapillaris and focal ischemic damage to the retinal pigment epithelium.[45] Hypertensive chorioretinopathy is thought to happen more commonly in younger patients due to the elasticity of their blood vessels.
The severity and duration of hypertension are directly proportional to the incidence of hypertensive retinopathy which is reported between 65-83% in different studies. Chronic kid-
ney disease has been found to be the most significant factor to predict severe hypertensive retinopathy.[44]
Acute manifestations of hypertensive retinopathy may manifest when the patient presents a very high systemic arterial pressure. Many young patients with secondary hypertension may actually present to an ophthalmologist with bilateral vision loss due to serous macular detachment, bilateral optic disc edema, and exudative retinal detachment. In addition, genetic factors have been found to be associated with a higher risk of hypertensive retinopathy. Chronic hypertensive retinopathy usually does not cause significant visual loss. The retinal changes can be halted when hypertension is treated. However, arteriolar narrowing and arteriovenous changes persist without significant effect on visual function; and if the blood pressure remains untreated, it can lead to vision loss within a short period of time. The cause of the vision loss is either due to retinal pigmentary changes or secondary to optic atrophy, neither of which is reversible.[44]
Possible complications of blood hypertension, associated with hypertensive retinopathy, may include retinal artery and/or vein occlusion, macro aneurysm of retinal arteriole, anterior ischemic optic neuropathy, suprachoroidal hemorrhage during ophthalmic surgery, increased risk and progression of diabetic retinopathy, glaucoma, and age-related macular degeneration.[42,44]
The main purpose of screening for hypertensive retinopathy is that retinal vessels are the only blood vessels visible on routine examination, providing relevant information for general physicians to timely manage hypertension to reduce the risk of ocular and systemic morbidity and mortality. [46] Hypertensive retinopathy is associated with an increased risk of stroke even after controlling blood pressure and other vascular risk factors.[43] Therefore the treatment of hypertensive retinopathy consists in treating blood hypertension. In particular, severe hypertensive retinopathy requires urgent treatment and referral as it has the strongest association with mortality.[47] Other systems such as renal, cardiovascular, and brain should be monitored.
Paracentral acute middle maculopathy (PAMM) is an optical coherence tomography finding seen in patients with retinal capillary ischemia and unspecific persistent scotomas. PAMM occurs as an isolated phenomenon or as a complicating feature either of an underlying retinal vasculopathy or a systemic disease. It is characterized by a hyper-reflective band-like lesion involving the inner nuclear layer, resulting in permanent inner nuclear layer thinning. [48] (Figure 3)
It seems to be due to sublethal ischemic hypoxia of the middle retinal tissue with changes in the intermediate and deep capillary plexuses, as identified by OCT angiography.[48,49] PAMM has been associated with a number of retinal vascular diseases, particularly with RVOs. It has been identified in cases of Purtscher’s retinopathy, sickle cell retinopathy and inflammatory occlusive retinal vasculitis, but also associated with inflammatory chorioretinopathies and cataract or vitreoretinal surgery.[48] In these cases it may be due to spasm or transient occlusion of the central retinal artery, particularly in patients with vasculopathic risk factors or cerebrovascular disease, or secondary to periocular anesthesia, that causes an increased orbital pressure and a reduction of flow through the central retinal artery.[50]
It has also been reported in several systemic conditions, including neuro-ophthalmic diseases and carotid arterial disease as well as secondary to vascular surgery. Finally, cases of isolated PAMM in otherwise healthy patients have been also described, supposing a link with past viral flu-like disease.[48]
Patients usually complain of sudden onset of one or multiple paracentral scotomata in one
Paracentral acute middle maculopathy (PAMM) is an op@cal coherence tomography finding seen in pa@ents with re@nal capillary ischemia and unspecific persistent scotomas. PAMM occurs as an isolated phenomenon or as complica@ng feature of an underlying re@nal vasculopathy or systemic disease. It is characterized by a hyper-reflec@ve band-like lesion involving the inner nuclear layer,




Figure 3. Optical coherence tomography scan passing through the fovea at baseline (A) showing a hyper-reflective band-like lesion involving the inner nuclear layer later disappearing at 1-month (B) and 1-year (C) follow-up, leaving a mild retinal focal thinning.
Op@cal coherence tomography scan passing through the fovea at baseline (A) showing a later disappearing at 1-month (B) and 1-year (C) follow-up, leaving a mild re@nal focal thinning.
or both eyes, which may be well identified with microperimetry and persist years after the first episode. Patients may also report blurred central vision or difficulty in focusing.[51] However, visual acuity may be either normal or slightly decreased and fundus examination may be negative. At OCT a hyperreflective band spanning the inner nuclear layer is visible, which progresses to atrophy over time, with inner nuclear layer thinning.[49] OCT angiography has made it possible to visualize the extent of ischemia in the intermediate and deep capillary plexus in the acute and chronic phases of PAMM. Conversely, FA less clearly distinguishes the
intermediate from the deep capillary plexus.[48]
As for other vascular occlusive retinal diseases, PAMM requires a complete systemic work out. However, to date, there is no specific treatment to revert PAMM, and treatment should be targeted at the underlying cause of PAMM, when present.
It is a rare condition, which is caused by ocular hypoperfusion due to severe carotid artery disease. Typically, a 90% or greater stenosis of the ipsilateral carotid arterial system is present, in fact, flow abnormalities within the vessel are seen when the stenosis reaches 70%, and it has been demonstrated that a 90% carotid stenosis reduces the ipsilateral central retinal artery perfusion pressure by about 50%.[52] The obstruction can be present within the common carotid or internal carotid artery. In some cases, obstruction of the ipsilateral ophthalmic artery can also be responsible for the ocular ischemic syndrome. Atherosclerosis within the carotid artery is the cause of the majority of the ocular ischemic syndrome cases. Dissecting aneurysms of the carotid artery has also been reported as well as giant cell arteritis. It usually involves old men (male: female ratio 2:1) with a mean age of 65 years. It may become bilateral in 20% of cases.[53,54] It is characterized by the abrupt or, more frequently, gradual loss of vision associated with dull aching pain, referred as “ocular angina”, due to ischemia of the globe, increased intraocular pressure and/or ischemia of the ipsilateral meninges.[55] Amaurosis fugax may present in about 15% of patients. Prognosis is not good, with more than half of the patients presenting with acuity inferior to 20/800 at one year follow-up.[55]
In the anterior segment, corneal edema and raised intraocular pressure are possible signs, associated to iris neovascularization which develops in a high percentage of cases (about 65%), but only half of these eyes then develop high intraocular pressure since poor ciliary body perfusion diminishes aqueous production in the others. Opalescence of the aqueous humor and inflammatory cells may also be identified. Major signs of the disease at the posterior segment are narrowed retinal arteries, dilated (non tortuous) veins, microaneurysm, retinal hemorrhages mostly located in the external retinal layers, at the mid-periphery, diffuse macular capillary telangiectasias, macular edema, cotton wool spots. A cherry-red spot, characteristic of retinal ischemia, mostly macular, is seen in 12% of eyes, predominantly when intraocular pressure exceeds the perfusion pressure within the central retinal artery in the eyes with neovascular glaucoma or in some cases as a result of embolic occlusion of the central retinal artery [3,5]. Retinal neovascularization may also occur, more often at the optic disk than in the retina. [56]
The most relevant diagnostic procedure in the diagnosis of ocular ischemic syndrome is FA which shows delayed choroidal filling and delayed arteriovenous transit time (in 95% of cases), as well as late arterial filling. Macula edema, retinal capillary non perfusion, microaneurysmal and optic nerve head hyperfluorescence are other additional findings. Electroretinography generally demonstrates a reduction in the amplitude of both the a- and b-waves.[55] Once diagnosis is made or suspected, carotid investigation and a systemic work-up are necessary since ocular ischemic syndrome is associated with systemic arterial hypertension, diabetes mellitus, atherosclerotic cardiac disease, previous stroke, peripheral arterial disease requiring bypass surgery and a 5-year mortality of 40% mostly due to cardiovascular disease.[56] When ocular ischemic syndrome is suspected, but Doppler ultrasound scan of the carotid arteries is within normal limits, investigation of retrobulbar vessels, especially of the ophthalmic artery, should be performed. Carotid arteriography is performed only in very advanced cases before planned surgery on the carotid arteries.[57]
The ophthalmological management of ocular ischemic syndrome aims to treat its compli-
cations, especially in the posterior segment, as they are associated with the highest risk of vision loss. Unfortunately, many of the consequences of the disease are irreversible. However, panretinal photocoagulation is indicated in patients with iris and posterior segment neovascularization to reduce retinal oxygen demand by ablation of the peripheral retina, preventing development of secondary neovascular glaucoma and intraocular hemorrhages. It may be difficult to perform because of the alterations also involving the anterior segment. Similarly, treatments of neovascular glaucoma and macular edema secondary to ocular ischemic syndrome require particular attention due to the fragility of the ocular tissues in these patients. [56] Causal treatment is the most appropriate approach. Early diagnosis and prompt treatment are crucial in reversal or stabilization of the symptoms. An expedited multidisciplinary approach between vascular surgery and ophthalmology services is necessary to facilitate timely treatment and optimize outcome. If diagnosed early, both carotid endarterectomy and carotid artery stenting have been associated with visual improvement and prevention of progressive visual loss.[58]
Performed at the early stages of neovascular glaucoma, by-pass surgery may result in regression of neovascularization at the angle and resolution of glaucoma. However, intraocular pressure may also increase after endarterectomy due to improved oxygen supply and restoration of normal production of aqueous humor by the ciliary body. Opting for a conservative treatment using aspirin and statin could be beneficial even in the early stage of presenting clinical evidence of the disease.[59]
Retinal arterial macroaneurysms (RAMs) are characterized by unilateral, solitary round or fusiform dilations of major retinal arteries within the first three orders of arteriolar bifurcation. They are acquired vascular dilatations of the large arterioles of the retina.
RAMs occur most often in women aged between 60 and 80 years, frequently associated with systemic findings such as hypertension, generalized arteriosclerosis and lipid anomalies.[60] Commonly, they are located at the site of an arteriolar bifurcation or an arteriovenous crossing at the posterior pole. The supratemporal artery is most commonly the site of RAMs; however, nasal arteries may be affected as well.[60] Multiple RAMs have been reported in 15-20% of affected eyes and may involve both eyes in about 10% of patients.[61]
Hypertensive and arteriosclerotic changes of arterial vessels due to ageing may explain the formation of RAM with the replacement of medial muscle fiber by collagen, hyaline degeneration of the vessel wall, endothelial cell damage with atheromas liming the inner wall leading to narrowing of the lumen, increased vessel rigidity, elevated intravasal pressure and transmural stress. Loss of autoregulation and blood flow turbulence are further circulatory disturbances. On the basis of these alterations, focal vessel dilatation and formation of RAMs occur.[62]
The majority of RAMs remain asymptomatic and are found by routine ophthalmoscopy. They may become symptomatic for two major reasons: first, progressive and chronic exudative processes involving the macula, and, rupture of the aneurysm as a result of high intravasal arterial pressure leading to intra-, sub-internal limiting membrane and vitreous hemorrhages. Valsalva maneuvers are thought to increase the risk of bleeding. Typically, patients experience a slow or sudden visual loss with/without floaters. Complex RAMs indicate an active vision-threatening process, and therapy should be considered. In fact, exudative or hemorrhagic complications involving the macula may cause significant visual deterioration and structural damage to the retinal tissue. They may lead to macular edema or extra- foveal retinal edema, serous retinal detachment, circinate figure and intraretinal hemorrhages sur-
rounding the aneurysm. “Hemorrhagic” RAM have showed a higher prevalence (66%) than exudative RAM (31%).[63]
Focal thrombosis and sclerosis lead to restoration of the vessel wall, and perfusion is preserved in most cases. Similarly, exudative retinopathy and hemorrhages may resolve. In cases involving the macula, visual restoration depends on the severity and duration of macular involvement. Structural damage from chronic cystoid edema, accumulation of lipid exudates and intraretinal hemorrhages is the most common cause of functional impairment. Other late complications of RAMs are epiretinal membrane and macular hole.[64]
The broad spectrum of clinical presentations and similarity to other retinal disorders often lead to initial misdiagnosis. At ophthalmoscopy, a focal fleshy saccular or fusiform thickening of the artery affected is visible. Clear diagnosis may be difficult if secondary exudative changes are present, obscuring the vessel anomaly. In those cases, angiography is indicated. FA shows a uniform filling in the early phase. Partial or incomplete filling is a sign of inner vessel wall thrombosis at the site of vessel dilatation. Blood flow may be restored completely and the vessel returns to normal.
Late phase angiography varies from little or no staining of the vessel wall to marked leakage into the adjacent retina. Microvascular anomalies surrounding RAMs can be found: a widening of the capillary-free zone around the vessel anomaly, adjacent capillary dilatation and non-perfusion, microaneurysms and small collateral vessels. Indocyanine angiography allows better visualization of deeper retinal and choroidal structures.[65]
Asymptomatic active or asymptomatic non-leaking RAMs should be monitored regularly to allow early diagnosis in case the disease should progress and threaten the macula. Although the overall prognosis (closure of RAM and visual restoration) is described as favorable, patients considered at a high risk of permanent structural damage of the macula should be considered for treatment. The main goal of therapy is to prevent or limit permanent visual loss due to exudative or hemorrhagic maculopathy. Various surgical options including laser and vitrectomy with a variety of additional measures have been suggested. However, up to now, no conclusive data exists that any therapy is of benefit/value. Thus, symptomatic, individual and logic-based decision-making should be considered in such cases.
The most popular therapeutic intervention for RAM is laser photocoagulation. More recently, intravitreal injections of anti-VEGF have been used as a treatment option for exudative/ hemorrhagic RAM or secondary macular edema. If there is a persistent hemorrhagic RAM with severe bleeding, pars plana vitrectomy might be considered.[63] In cases of subretinal hemorrhage involving macula, pneumatic displacement or submacular surgery might be performed. During surgery, tPA may be utilized to assist in hemorrhage clearance. Preretinal hemorrhage typically resolves with observation alone, but the presence of dense preretinal blood can cause epiretinal membrane formation. When hemorrhage under the inner limiting membrane occurs, YAG laser could be effectively used to release the trapped blood into the vitreous for quicker absorption.[63]
Idiopathic juxtafoveolar retinal telangiectasia (IJRT) refers to a heterogeneous group of well-recognized clinical entities characterized by telangiectatic alterations of the juxtafoveolar capillary network of one or both eyes, but which differ in appearance, presumed pathogenesis, and management strategies.[66] They were first classified by Gass and Oyakawa in 1982 using biomicroscopic and FA data.[67] This classification was updated by Gass and Blodi in 1993, who subdivided IJRT into three groups.[68] Group 1 IJRT are congenital and unilateral in most cases and characterized by dilated retinal capillaries and abnormal leakage leading
to an easily visible exudation. Group 2 IJRT are mostly bilateral and characterized by atrophy of the fovea. Group 3 IJRT are extremely rare and characterized by progressive obliteration of the perifoveal capillary network. Each main group had a presumed independent etiology. This classification, based on clinical examination and angiographic findings, comprised additional staging for IJFT group II into five stages, and proposed observations and pathogenetic mechanisms which continue to be validated today with more modern imaging modalities and functional studies. Yannuzzi et al. proposed a simplified classification of IJFT.[69] Type 1 or “aneurysmal telangiectasia” equivalent to IJFT group I and type 2 or “perifoveal telangiectasia” equivalent to IJFT group IIA, the most common type of IJFT. The remaining types described by Gass and Blodi were omitted from Yannuzzi’s classification because of their rarity. Type 1 IJRT occurs predominantly in males and is typically unilateral. The mean age of onset is 40 years. At fundus examination, prominent easily visible telangiectatic retinal capillaries, with variable-sized aneurysmal dilations are characteristic with telangiectasis usually involving a two-disc diameter area or greater temporal to the fovea. Macular edema and lipid deposition of variable amount is a characteristic feature. At FA the telangiectatic vessels are easily visible. Minimal nonperfusion or capillary ischemia may also be detected. (Figure 4)
Macular edema and exudation are the main cause of visual loss in these patients. However, the amount of exudation, cystoid macular edema, and subsequent visual acuity loss is variable.[67,69] Focal vascular changes may develop also in the periphery. In fact, this group of IJFT may be a localized form or part of the spectrum of congenital retinal telangiectasis or Coats’ disease, identical to what Leber had previously described as miliary aneurysms of the retina.[66,67,69] Treatment options for IJFT I include laser photocoagulation, intravitreal injections of steroids, or anti-VEGF agents. Photocoagulation should be used sparingly to reduce the chance of producing a symptomatic paracentral scotoma and metamorphopsia. The optimal treatment of IJFT I is under discussion, and decided on single case’s characteristics.[66]
Type 2 IJFT is now known as idiopathic perifoveal telangiectasis or idiopathic Mac Tel 2.[70] Mac Tel 2 is a bilateral condition that usually presents at 50-60 years of age. Regarding the incidence, no sex or race difference has been observed. Up to 45% of patients with Mac Tel 2


may have evidence of a systemic disorder most commonly diabetes mellitus.[71] Despite this, the true relationship between Mac Tel 2 and diabetes is still uncertain. Other reported associations of Mac Tel 2 include celiac sprue, hypertension, polycythemia vera, coronary artery disease, Alport disease, CREST syndrome, and pseudoxanthoma elasticum.[70]
Main visual symptoms are mild blurring of vision, positive scotoma, difficulty in reading, and metamorphopsia. However, the disease is characterized by relatively good visual acuities of ≥20/30. In contrast, microperimetric data have shown scotomas next to fixation with good topographic correspondence to the angiographic, OCT, and ophthalmoscopic alterations.[72]
The earliest ophthalmoscopic changes seen in Mac Tel 2 are a mild grayish discoloration of the retina with loss of retinal transparency temporal to the fovea. This parafoveal graying, seems to be secondary to ischemia and nutritional damage to the middle layers of the retina, more than to edema.[73] With the progression of the disease , slightly dilated and blunted retinal venules that extend at right angles into the temporal parafoveolar retina appear. Telangiectatic vessels typically are not associated with lipid exudation or hemorrhages. Multiple golden, tiny, crystalline refractile deposits near the inner retinal surface occur in up to 45% of eyes. Focal atrophy of the foveolar retina may create a lamellar macular hole.[70]
Classic angiographic findings in Mac Tel 2 are dilated, ectatic capillaries that leak dye in the parafoveal temporal areas. In the early stages of the disease, the early phases of the angiogram show minimal or no evidence of capillary dilatation. There is mild staining of the temporal outer parafoveal retina in the late phases that spares the foveal center. As the disease progresses the capillary dilatation and permeability changes in the outer retina extend beyond the temporal parafoveal area. This is manifested as a late, oval-shaped parafoveal hyperfluorescence.[69] OCT has proved that angiographic areas of leakage do not correlate with the presence of retinal thickening. A common observation in OCT images are intraretinal hyporeflective spaces that are usually not correlated with retinal thickening, visual acuity, FA, or biomicroscopic findings.[74] Plaques of pigment epithelium hyperplasia may be visible in OCT scans as highly reflective areas within the inner retina with underlying shadowing.[73]
Conclusions regarding the pathogenesis of Mac Tel 2 have been limited by the available imaging technologies and the small number of histopathological specimens. Mac Tel 2 has previously been considered as a primary retinal vascular disorder. However more recent observations have implicated that Müller cells play a central role in pathogenesis. Based on current imaging modalities, Mac Tel 2 appears to be a primary neuroretinal degenerative condition with a secondary vascular involvement.[70] In fact, as Mac Tel 2 progresses, secondary vascular changes appear. The structural capillary changes may lead to hypoxia, which may stimulate VEGF secretion. In some, but not all, eyes, subretinal neovascularization may develop. Currently there is no treatment available to alter the progression of this disease. Although there are some therapies that seem to limit the subretinal neovascularization in the final proliferative stage, previous stages are still untreatable.
IJFT group 3 described by Gass was characterized by progressive bilateral perifoveolar capillary obliteration, capillary telangiectasis, minimal exudation clinically and on angiography and visual loss in association with systemic or cerebral familial disease. This has been omitted in the recent classification of IJFT due to its rarity.[69]
There is a wide range of arteriovenous anastomoses in the retina, from small uncomplicated short-circuits to hugely dilated ones. Small anastomoses are usually non-symptomatic; large ones are associated with cerebral anomalies in up to 90% of cases. Loss of vision is often the initial symptom, usually caused by central nervous damage. (Figure 5)

Figure 5. Fundus photo and fluorescein angiography of case of a mild arteriovenous anastomosis, casually detected in an adolescence girl.

From the mid-1920s onward, there were increasing numbers of reports on the simultaneous occurrence of retinal and cerebral arteriovenous anastomoses.[75,76] In 1943 R. Wyburn-Mason described a clinical entity consisting of retinal and intracerebral vascular abnormalities.[77] Wyburn-Mason syndrome is a rare congenital oculocerebral syndrome consisting of retinal arteriovenous anastomoses and ipsilateral cerebral arteriovenous vascular abnormalities. It may, but does not always, also involve nevi and vascular malformations in the skin and mucosa in the area of the trigeminal nerve. Wyburn-Mason syndrome is one of the phacomatoses.
Arteriovenous anastomoses are congenital vascular malformations. They arise due to disturbances in the maturation process of the retinal vascular system. Individual or multiple short-circuits of widely varying caliber develop between the arteries and veins in the retina. The surface extension of the malformation is also extremely variable, ranging from the involvement of small sectors to involvement of the entire retina.[78] It has been classified in three main forms: firstly, arteriovenous anastomoses in which normal capillaries, or at least one more or less normal capillary plexus, are present between the arteries and veins; and, secondly, arteriovenous anastomoses with a direct transition from arteries to veins, without intermediate capillary or arteriolar links.[79] Moreover, in group 2 small and circumscribed arteriovenous anastomoses, completely without retinal complications, or with comparatively few are included. Vision is usually good. It is exceptional to find this combined with cerebral vascular anomalies. In group 3 the anastomoses are extremely extensive, complex, and produce severe retinal complications. Cerebral involvement is usually found.[80] The arteriovenous anastomoses that occur in Wyburn-Mason syndrome belong exclusively to group 2 and mostly 3.
Arteriovenous anastomoses occur with equal frequency in both sexes. They are usually identified in adolescence, but can already be present in neonates. They occur in a strictly unilateral pattern.
The location of preference is the central or temporal retina. Individual vascular loops can reach as far as the perifoveal arcades, and sometimes even into the fovea itself. A cilioretinal artery is sometimes incorporated into the arteriovenous vascular loop. The anastomotic vessels can be 60-150 µm in diameter. In severe cases the anastomoses can develop huge, contorted shapes. The vessels are intertwined and convoluted. They can reach a diameter up to 10-12 times that of normal retinal vessels. They usually spread over the entire fundus. The dilated anastomotic vessels may hide the optic disk completely. Occasionally the anastomosis is limited to the disk area [64]. Even extremely dilated vessels do not show any pulsations. Large vascular diameter creates a high flow rate, so that the venous side of the anastomosis also carries oxygenated blood. The arterial and venous vascular limbs are often only distinguishable angiographically. The intravascular pressure is increased, and damage to the vascular walls consequently develops over time. The anastomoses develop white-yellowish sheathings and are accompanied by serous exudates, lipid deposits, and reactive pigmentary hyperplasia. Bleeding can also occur. [81] In contrast to other retinal vascular diseases, usually the avascular areas do not stimulate neovascularization.
Loss of vision is rare in cases of simple anastomoses, and only arises when the macula or optic nerve is involved. In the severe forms, by contrast, visual field defects and loss of vision of varying degree, ranging up to complete blindness, usually develop. The functional deficits are usually due to the cerebral or orbital vascular changes. Overall, two-thirds of patients with anastomoses have functional defects.
Fluorescein imaging reveals the extremely high blood flow velocity in the arteriovenous anastomoses. The larger the vascular diameter, the higher the flow rate. If damage to the vascular walls develops over time the angiogram shows dye leakage from the dilated vessels which can even extend to complete collapse of the blood retinal barrier. Arteriovenous anastomoses are regarded as being static and unchanging. However, spontaneous remissions have been noted during long-term observations.[82]
The histological appearance of arteriovenous anastomoses is that of hypertrophic, normally matured blood vessels [70]. The vessels extend into all layers of the retina. Larger anastomoses bulge into the vitreous cavity and may also come into contact externally with Bruch’s membrane. Segments of the vascular walls may be either thinned or thickened. Dilated
arteries and veins are histopathologically barely distinguishable from one another. The vascular walls are fibrotic and interspersed with hyaline and lipid infiltrations. The surrounding retina shows cystoid changes and loss of ganglia cells and axons.[76,83]
Retinal arteriovenous anastomoses may be associated with analogous vascular malformations in the orbit and central nervous system, and more rarely with mucous and cutaneous vascular changes in the face. Cerebral malformations and retinal anastomoses are strictly ipsilateral in location and mainly appear to involve the complete optic tract as far as the optic cortex.[84] In the cerebral region as well, the spectrum of arteriovenous aneurysms and angiomas ranges from small and medium-sized to extensive e and voluminous malformations.
Treatment for retinal arteriovenous anastomoses is not required, or not possible. In cases of threatening central retinal vein occlusion, early photocoagulation should be carried out. An interdisciplinary examination including neurological and neurosurgical consultation, with computed tomography or magnetic resonance imaging, is absolutely imperative, at least for patients with larger anastomoses [78]
Putscher’s retinopathy is a traumatic retinal angiopathy and was originally described in individuals with severe head trauma.[85] Usually occurs in both eyes but unilateral cases have been described.
The term Purtscher’s like retinopathy is currently used to describe similar fundus findings associated with various conditions: trauma (head trauma, compressive chest injuries, long bone fractures with fat embolism), collagen vascular diseases (systemic lupus erythematosus, sclerodermia, dermatomyositis), kidney disease, and childbirth (amniotic fluid embolism). Although associated with several systemic conditions, Purtscher’s retinopathy is a relatively uncommon finding.[86,87]
Several authors have hypothesized that microembolic events, such as fat embolization in the long bone fractures and air embolization from compressive chest injuries, may be responsible.[88] Others speculate that venous reflux with capillary engorgement of the upper body plays a role.[89]
Studies have shown that leukocyte aggregation by activated complement factors may lead to leukocyte emboli that can occlude the peripapillary retinal capillaries in conditions such as trauma, acute pancreatitis, and collagen vascular diseases.[90] Acute funduscopic findings include cotton wool spots and intraretinal hemorrhages, primarily located in the posterior pole. Optic disk swelling may also occur. (Figure 6)
FA may reveal focal retinal arteriolar occlusions in the perifoveal area, capillary non-perfusion, and leakage from vessels in the areas of infarction.[91]
Visual acuity is markedly decreased in the affected eyes and may range from 20/200 to light perception. An afferent papillary defect may be present if the condition is unilateral or asymmetric.
Differentiating between Purtscher’s retinopathy and other conditions requires a thorough medical history to document preexisting medical conditions, such as diabetes and hypertension, and possible precipitating events such as trauma, that may help in the differential diagnosis. In addition, funduscopic findings such as lipid exudates, tortuous and dilated veins, and retinal neovascularization are not typical.
Visual outcomes in Purtscher’s retinopathy are variable, depending on the location and amount of capillary non-perfusion, involvement of the macula and the occurring degree of optic atrophy.


Currently, there is no well-defined treatment for Purtscher’s retinopathy. Initial treatment is supportive and aimed at resolving the underlying medical condition. Although steroid therapy has been proposed for the treatment of Purtscher’s retinopathy, in hope that steroids can stabilize damaged tissue and perhaps block the formation of complement-activated leukocyte aggregation, no conclusive evidences have determined the superiority of this type of treatment.[92]
Terson’s syndrome
Intraretinal hemorrhage associated with subarachnoid hemorrhage was first described by Moritz Litten in 1881 and later defined by Albert Terson as vitreous hemorrhage secondary to subarachnoid or subdural hemorrhage. Subarachnoid bleeding is the most common cause, then subdural hemorrhage, which is often associated with brain trauma and permanent neurological or mental disability. The definition of Terson’s syndrome has been widened to include any intraocular hemorrhage caused by acute intracranial hypertension.[93]
Screening of patients with subarachnoid or subdural hemorrhage through the dilated pupil should be part of these patients’ management protocol. Presence of intraocular hemorrhage in patients with subarachnoid hemorrhage is a poor prognostic sign, being a statistically significant risk factor for coma as well as for death.[94]
Since pressure is elevated in each distal vein, hemorrhage can occur anywhere (multilayered intraocular hemorrhages): within the sheath of the optic nerve, in the orbit, and, most importantly, intraocularly. Blood inside the globe can appear in one or multiple locations: subretinal, intraretinal, preretinal (subhyaloidal) and intravitreal. It may be bilateral or involving both eyes.
The origin of intraocular hemorrhage in Terson’s Syndrome is debated. It is generally caused by or linked to conditions that trigger an acute increase in intracranial pressure, leading to the bursting of small retinal vessels. Both aneurysmal and non-aneurysmal origins have been described. Other theories refer to direct penetration through the lamina cribrosa, damage to the peripapillary tissue, entry through the perivascular spaces and a vitreous origin of the
blood. It has also been suggested that an acutely raised ICP induces effusion of cerebrospinal fluid into the optic nerve sheath which dilates the retrobulbar aspect of the sheath in the orbit. Dilatation mechanically compresses the central retinal vein and retinochoroidal veins resulting in venous hypertension and rupture of thin retinal vessels.[94,95]
Patients report a decrease in visual acuity and blurred vision due to obstruction of the visual axis by the intraocular hemorrhage. The diagnosis is made using clinical presentation and fundus examination. Ocular sonography has a specificity of up to 100% in detecting Terson’s Syndrome.[96] Computed tomography orbital thin cuts without contrast can visualize hyperdense intraocular collection behind or within the vitreous suggestive of hemorrhages. Magnetic Resonance Imaging (MRI) sequences may detect thin intraocular blood.[94]
The vitreous hemorrhage may take months to spontaneously improve, but observation has been recommended only for mild unilateral hemorrhages. Possible complications include: epiretinal membrane, macular hole, retinal detachment, proliferative vitreoretinopathy. Regular ophthalmologic examinations are needed to monitor the development of complications such as retinal detachment. Vitrectomy, aimed at removal of the intravitreal blood, has proved to be efficient in adults, however, the literature differs in the ideal time for surgery. The timing of vitrectomy is primarily determined by the patient’s needs and wishes, but early intervention should be considered for eyes without spontaneous signs of blood resorption. Alternative treatment using laser hyaloidotomy and intravitreal injection therapies should be considered if a conservative approach and vitrectomy fails.[94]
References
1. Scott IU, Campochiaro PA, Newman NJ, Biousse V. Retinal vascular occlusions. Lancet (London, England). 2020;396:1927–40.
2. MacGrory B, Schrag M, Biousse V, et al. Management of Central Retinal Artery Occlusion: A Scientific Statement From the American Heart Association. Stroke. 2021;52:E282–94.
3. Park SJ, Choi NK, Seo KH, Park KH, Woo SJ. Nationwide incidence of clinically diagnosed central retinal artery occlusion in Korea, 2008 to 2011. Ophthalmology. 2014;121:1933–8.
4. Liu W, Bai D, Kou L. Progress in central retinal artery occlusion: a narrative review. J Int Med Res. 2023;51.
5. Hayreh SS, Podhajsky PA, Zimmerman MB. Retinal artery occlusion: associated systemic and ophthalmic abnormalities. Ophthalmology. 2009;116:1928–36.
6. Anderson DC, Kappelle LJ, Eliasziw M, Babikian VL, Pearce LA, Barnett HJM. Occurrence of hemispheric and retinal ischemia in atrial fibrillation compared with carotid stenosis. Stroke. 2002;33:1963–7.
7. Tiwari V, Bagga SSJ, Prasad R, Mathurkar S. A Review of Current Literature on Central Retinal Artery Occlusion: Its Pathogenesis, Clinical Management, and Treatment. Cureus. 2024;16.
8. Hayreh SS, Jonas JB. Optic disk and retinal nerve fiber layer damage after transient central retinal artery occlusion: An experimental study in rhesus monkeys. Am J Ophthalmol. 2000;129:786–95.
9. Hayreh SS, Zimmerman MB, Kimura A, Sanon A. Central retinal artery occlusion. Retinal survival time. Exp Eye Res. 2004;78:723–36.
10. Hayreh SS, Zimmerman MB. Central retinal artery occlusion: visual outcome. Am J Ophthalmol. 2005;140:376.e1-376.e.
11. Hayreh SS. Acute retinal arterial occlusive disorders. Prog Retin Eye Res. 2011;30:359–94.
12. Wenzel DA, Kromer R, Poli S, et al. Optical coherence tomography-based determination of ischaemia onset - the temporal dynamics of retinal thickness increase in acute central retinal artery occlusion. Acta Ophthalmol. 2021;99:e247–52.
13. De Castro-Abeger AH, De Carlo TE, Duker JS, Baumal CR. Optical Coherence Tomography Angiography Compared to Fluorescein Angiography in Branch Retinal Artery Occlusion. Ophthalmic Surg Lasers Imaging Retina. 2015;46:1052–4.
14. Murphy-Lavoie H, Butler F, Hagan C. CRAo TREATED WITH HBo 2 Central retinal artery occlusion treated with oxygen: A literature review and treatment algorithm. 2012;39.
15. MacGrory B, Nackenoff A, Poli S, et al. Intravenous Fibrinolysis for Central Retinal Artery Occlusion: A Cohort Study and Updated Patient-Level Meta-Analysis. Stroke. 2020;51:2018–25.
16. Michel J. Die spontane Thrombose der Vena centralis des Opticus. Albr von Græfe’s Arch für Ophthalmol. 1878;24:37–70.
17. R L. Ophthalmologische Notizen. 3. Apoplexia retinae. Graefe’s Arch Clin Exp Ophthalmol. 1855;1:346–51.
18. GC B. Central retinal vein onstrucion: diagnosis and management. In: (ed) RR, editor. Ophthalmol Annual. 1985. p. 65–97.
19. Ip M, Hendrick A. Retinal Vein Occlusion Review. Asia-Pacific J Ophthalmol (Philadelphia, Pa). 2018;7:40–5.
20. Hayreh SS. Classification of central retinal vein occlusion. Ophthalmology. 1983;90:458–74.
21. Baseline and early natural history report. The Central Vein Occlusion Study. Arch Ophthalmol (Chicago, Ill 1960). 1993;111:1087–95.
22. Schmidt-Erfurth U, Garcia-Arumi J, Gerendas BS, et al. Guidelines for the Management of Retinal Vein Occlusion by the European Society of Retina Specialists (EURETINA). Ophthalmologica. 2019;242:123–62.
23. Hayreh SS, Klugman MR, Beri M, Kimura AE, Podhajsky P. Differentiation of ischemic from non-ischemic central retinal vein occlusion during the early acute phase. Graefes Arch Clin Exp Ophthalmol. 1990;228:201–17.
24. Chan CK, Ip MS, Vanveldhuisen PC, et al. SCORE Study report #11: incidences of neovascular events in eyes with retinal vein occlusion. Ophthalmology. 2011;118:1364–72.
25. LL H. Behandlungsmöglichkeiten bei Zentralvenenverschlüssen. Ophthalmologe. 1994;91:131–45.
26. A Randomized Clinical Trial of Early Panretinal Photocoagulation for Ischermic Central Vein Occlusion: The Central Vein Occlusion Study Group N Report. Ophthalmology. 1995;102:1434–44.
27. Rosenberg NR. Argon laser scatter photocoagulation for prevention of neovascularization and vitreous hemorrhage in branch vein occlusion. A randomized clinical trial. Branch Vein Occlusion Study Group. Arch Ophthalmol (Chicago, Ill 1960). 1986;104:34–41.
28. Scott IU, Ip MS, VanVeldhuisen PC, et al. A randomized trial comparing the efficacy and safety of intravitreal triamcinolone with standard care to treat vision loss associated with macular Edema secondary to branch retinal vein occlusion: the Standard Care vs Corticosteroid for Retinal Vein Occlusion (SCORE) study report 6. Arch Ophthalmol (Chicago, Ill 1960). 2009;127:1115–28.
29. Haller JA, Bandello F, Belfort R, et al. Randomized, sham-controlled trial of dexamethasone intravitreal implant in patients with macular edema due to retinal vein occlusion. Ophthalmology. 2010;117.
30. Haller JA, Bandello F, Belfort R, et al. Dexamethasone intravitreal implant in patients with macular edema related to branch or central retinal vein occlusion twelve-month study results. Ophthalmology. 2011;118:2453–60.
31. Campochiaro PA, Brown DM, Awh CC, et al. Sustained benefits from ranibizumab for macular edema following central retinal vein occlusion: twelve-month outcomes of a phase III study. Ophthalmology. 2011;118:2041–9.
32. Heier JS, Campochiaro PA, Yau L, et al. Ranibizumab for macular edema due to retinal vein occlusions: long-term follow-up in the HORIZON trial. Ophthalmology. 2012;119:802–9.
33. Brown DM, Campochiaro PA, Singh RP, et al. Ranibizumab for macular edema following central retinal vein occlusion: sixmonth primary end point results of a phase III study. Ophthalmology. 2010;117:1133.e1.
34. Brown DM, Campochiaro PA, Bhisitkul RB, et al. Sustained benefits from ranibizumab for macular edema following branch retinal vein occlusion: 12-month outcomes of a phase III study. Ophthalmology. 2011;118:1594–602.
35. Campochiaro PA, Clark WL, Boyer DS, et al. Intravitreal aflibercept for macular edema following branch retinal vein occlusion: the 24-week results of the VIBRANT study. Ophthalmology. 2015;122:538–44.
36. Heier JS, Clark WL, Boyer DS, et al. Intravitreal aflibercept injection for macular edema due to central retinal vein occlusion: two-year results from the COPERNICUS study. Ophthalmology. 2014;121:1420.e1.
37. Ogura Y, Roider J, Korobelnik JF, et al. Intravitreal aflibercept for macular edema secondary to central retinal vein occlusion: 18-month results of the phase 3 GALILEO study. Am J Ophthalmol. 2014;158:1032–8.
38. Scott IU, VanVeldhuisen PC, Ip MS, et al. Effect of Bevacizumab vs Aflibercept on Visual Acuity Among Patients With Macular Edema Due to Central Retinal Vein Occlusion: The SCORE2 Randomized Clinical Trial. Jama. 2017;317:2072–87.
39. Scott IU, VanVeldhuisen PC, Ip MS, et al. Baseline Factors Associated With 6-Month Visual Acuity and Retinal Thickness Outcomes in Patients With Macular Edema Secondary to Central Retinal Vein Occlusion or Hemiretinal Vein Occlusion: SCORE2 Study Report 4. JAMA Ophthalmol. 2017;135:639–49.
40. Hayreh SS, Klugman MR, Podhajsky P, Servais GE, Perkins ES. Argon laser panretinal photocoagulation in ischemic central retinal vein occlusion. A 10-year prospective study. Graefes Arch Clin Exp Ophthalmol. 1990;228:281–96.
41. Song P, Xu Y, Zha M, Zhang Y, Rudan I. Global epidemiology of retinal vein occlusion: a systematic review and meta-analysis of prevalence, incidence, and risk factors. J Glob Health. 2019;9.
42. Tsukikawa M, Stacey AW. <p>A Review of Hypertensive Retinopathy and Chorioretinopathy</p>. Clin Optom. 2020;12:67–73.
43. Henderson AD, Bruce BB, Newman NJ, Biousse V. Hypertension-related eye abnormalities and the risk of stroke. Rev Neurol Dis. 2011;8:1.
44. Shaheen AR, Sridhar J. Hypertensive Retinopathy. Retin Choroidal Vasc Dis Eye. 2023;427–36.
45. Tso MOM, Jampol LM. Pathophysiology of hypertensive retinopathy. Ophthalmology. 1982;89:1132–45.
46. Fraser-Bell S, Symes R, Vaze A. Hypertensive eye disease: a review. Clin Experiment Ophthalmol. 2017;45:45–53.
47. Keith NM, Wagener HP, Barker NW. Some different types of essential hypertension: their course and prognosis. Am J Med Sci. 1974;268:336–45.
48. Moura-Coelho N, Gaspar T, Ferreira JT, Dutra-Medeiros M, Cunha JP. Paracentral acute middle maculopathy-review of the literature. Graefes Arch Clin Exp Ophthalmol. 2020;258:2583–96.
49. Rahimy E, Kuehlewein L, Sadda SR, Sarraf D. Paracentral Acute Middle Maculopathy: What We Knew Then and What We Know Now. Retina. 2015;35:1921–30.
50. Pham C, Boo A, Chew SKH, Okada M. Paracentral acute middle maculopathy in a young patient following routine phacoemulsification surgery. Clin Experiment Ophthalmol. 2019;47:1206–9.
51. Shah A, Rishi P, Chendilnathan C, Kumari S. OCT angiography features of paracentral acute middle maculopathy. Indian J Ophthalmol. 2019;67:417–9.
52. Kobayashi S, Hollenhorst RW, Sundt TM. Retinal arterial pressure before and after surgery for carotid artery stenosis. Stroke. 1971;2:569–75.
53. Duker JS, Belmont JB. Ocular ischemic syndrome secondary to carotid artery dissection. Am J Ophthalmol. 1988;106:750–2.
54. Hamed LM, Guy JR, Moster ML, Bosley T. Giant cell arteritis in the ocular ischemic syndrome. Am J Ophthalmol. 1992;113:702–5.
55. Brown GC, Magargal LE. The ocular ischemic syndrome. Clinical, fluorescein angiographic and carotid angiographic features. Int Ophthalmol. 1988;11:239–51.
56. Terelak-Borys B, Skonieczna K, Grabska-Liberek I. Ocular ischemic syndrome - a systematic review. Med Sci Monit. 2012;18.
57. Sharma S BG. Ocular Ischemic Syndrome. In: Elsevier E, editor. Ryan SJ, Hinton DR, Schachat AP et al. 2006. p. 1491–502.
58. Suhail S, Tallarita T, Kanzafarova I, et al. Ocular Ischemic Syndrome and the Role of Carotid Artery Revascularization. Ann Vasc Surg. 2024;105:165–76.
59. Gkiala A, Zaheer N, Anwar S, Perera S, Sharara A, Lip PL. Is a Carotid Doppler Scan Useful for Managing Patients with Suspected Ocular Ischemic Syndrome? Clin Ophthalmol. 2024;18:2041–8.
60. Moosavi RA, Fong KCS, Chopdar A. Retinal artery macroaneurysms: clinical and fluorescein angiographic features in 34 patients. Eye (Lond). 2006;20:1011–20.
61. Rabb MF, Gagliano DA, Teske MP. Retinal arterial macroaneurysms. Surv Ophthalmol. 1988;33:73–96.
62. Fichte C, Streeten BW, Friedman AH. A histopathologic study of retinal arterial aneurysms. Am J Ophthalmol. 1978;85:509–13.
63. Chen H, Zhao X yu, Meng L hui, Zhang W fei, Chen Y xin. Clinical characteristics of retinal arterial macroaneurysms and prognosis of different interventions. Graefes Arch Clin Exp Ophthalmol. 2022;260:439–50.
64. Tashimo A, Mitamura Y, Ohtsuka K, Okushiba U, Imaizumi H, Takeda M. Macular hole formation following ruptured retinal arterial macroaneurysm. Am J Ophthalmol. 2003;135:487–92.
65. Townsend-Pico WA, Meyers SM, Lewis H. Indocyanine green angiography in the diagnosis of retinal arterial macroaneurysms associated with submacular and preretinal hemorrhages: A case series. Am J Ophthalmol. 2000;129:33–7.
66. Nowilaty SR, Al-Shamsi HN, Al-Khars W. Idiopathic Juxtafoveolar Retinal Telangiectasis: A Current Review. Middle East Afr J Ophthalmol. 2010;17:224.
67. Gass D, Oyakawa RT. Idiopathic juxtafoveolar retinal telangiectasis. Arch Ophthalmol (Chicago, Ill 1960). 1982;100:769–80.
68. Gass JDM, Blodi BA. Idiopathic Juxtafoveolar Retinal Telangiectasis: Update of Classification and Follow-up Study. Ophthalmology. 1993;100:1536–46.
69. Yannuzzi LA, Bardal AMC, Freund KB, Chen KJ, Eandi CM, Blodi B. Idiopathic macular telangiectasia. Arch Ophthalmol (Chicago, Ill 1960). 2006;124:450–60.
70. Wu L, Evans T, Arevalo JF. Idiopathic macular telangiectasia type 2 (idiopathic juxtafoveolar retinal telangiectasis type 2A, Mac Tel 2). Surv Ophthalmol. 2013;58:536–59.
71. Clemons TE, Gillies MC, Chew EY, et al. Baseline Characteristics of Participants in the Natural History Study of Macular Telangiectasia (MacTel) MacTel Project Report No. 2. Ophthalmic Epidemiol. 2010;17:66.
72. Charbel Issa P, Helb HM, Rohrschneider K, Holz FG, Scholl HPN. Microperimetric assessment of patients with type 2 idiopathic macular telangiectasia. Invest Ophthalmol Vis Sci. 2007;48:3788–95.
73. Cohen SM, Cohen ML, El-Jabali F, Pautler SE. Optical coherence tomography findings in nonproliferative group 2a idiopathic juxtafoveal retinal telangiectasis. Retina. 2007;27:59–66.
74. Koizumi H, Iida T, Maruko I. Morphologic features of group 2A idiopathic juxtafoveolar retinal telangiectasis in three-dimensional optical coherence tomography. Am J Ophthalmol. 2006;142:340–3.
75. EHLERS H. ANEURYSMA RACEMOSUM ARTERIOVENOSUM RETINAE. Acta Ophthalmol. 1924;2:374–87.
76. KRUG EF, SAMUELS B. VENOUS ANGIOMA OF THE RETINA, OPTIC NERVE, CHIASM AND BRAIN: A CASE REPORT WITH POSTMORTEM OBSERVATIONS. Arch Ophthalmol. 1932;8:871–9.
77. Wyburn-mason R. ARTERIOVENOUS ANEURYSM OF MID-BRAIN AND RETINA, FACIAL NÆVI AND MENTAL CHANGES. Brain. 1943;66:163–203.
78. Schmidt D, Pache M, Schumacher M. The Congenital Unilateral Retinocephalic Vascular Malformation Syndrome (BonnetDechaume-Blanc Syndrome or Wyburn-Mason Syndrome): Review of the Literature. Surv Ophthalmol. 2008;53:227–49.
79. Archer DB, Deutman A, Ernest JT, Krill AE. Arteriovenous Communications of the Retina. Am J Ophthalmol. 1973;75:224–41.
80. Archer DB, Amoaku WM, Gardiner TA. Radiation retinopathy--clinical, histopathological, ultrastructural and experimental correlations. Eye (Lond). 1991;5 ( Pt 2):239–51.
81. Mansour AM, Wells CG, Jampol LM, Kalina RE. Ocular complications of arteriovenous communications of the retina. Arch Ophthalmol (Chicago, Ill 1960). 1989;107:232–6.
82. Jeanmart L, Brihaye J, Retif J. [Isolated and unilateral arteriovenous anastomosis of the retina with a 25-year follow-up]. Bull Soc Belge Ophtalmol. 1987;225 Pt 2:145–54.
83. François J, Rabaey M. [Preretinal hemosiderosis and arteriovenous aneurysm]. Ophthalmologica. 1951;122:348–56.
84. De Laey JJ, Hanssens M. Congenital arteriovenous communications in the retina. Vasc Tumors Malformations Ocul Fundus. 1990;85–99.
85. Purtscher O. Noch Unbekannte Befunde Nach Schadeltrauma. Bericht Uber Die Zusammenkunft Der Dtsch Ophthalmol Gesellschaft. 1910;36:294–301.
86. Blodi BA, Johnson MW, Gass JDM, Fine SL, Joffe LM. Purtscher’s-like retinopathy after childbirth. Ophthalmology. 1990;97:1654–9.
87. Agrawal A, McKibbin MA. Purtscher’s and Purtscher-like retinopathies: A review. Surv Ophthalmol. 2006;51:129–36.
88. Burton TC. Unilateral Purtscher’s retinopathy. Ophthalmology. 1980;87:1096–105.
89. Mark WG, Marr EG. Some Observations on Purtscher’s Disease: Traumatic Retinal Angiopathy. Am J Ophthalmol. 1962;54:693–705.
90. Bleich HL, Moore MJ, Jacob HS, Craddock PR, Hammerschmidt DE, Moldow CF. Complement-induced granulocyte aggregation: an unsuspected mechanism of disease. N Engl J Med. 1980;302:789–94.
91. Gass JDM (John DM. Stereoscopic atlas of macular diseases : diagnosis and treatment. 1977;411.
92. Xia D, Chen X, Zhou Q, et al. Efficacy of Purtscher’s Retinopathy Treatments: A Systematic Review. Curr Eye Res. 2017;42:908–17.
93. A. T. De l’hemorrhage dans le corps vitre au cours de l’hemorrhage cerebrale. Clin Ophthalmol. 1900;6:309–12.
94. Aboulhosn R, Raju B, Jumah F, et al. Terson’s syndrome, the current concepts and management strategies: A review of literature. Clin Neurol Neurosurg. 2021;210:107008.
95. Hayreh SS. Pathogenesis of Terson syndrome. Indian J Ophthalmol. 2022;70:4130–7.
96. Czorlich P, Burkhardt T, Knospe V, et al. Ocular ultrasound as an easy applicable tool for detection of Terson’s syndrome after aneurysmal subarachnoid hemorrhage. PLoS One. 2014;9.
Mastropasqua, Lisa Toto, Rossella D’Aloisio, Marialudovica Ruggeri, Anna Romano
Acquired immunodeficiency syndrome (AIDS) is a potentially fatal multisystem syndrome with HIV infection leads to a slow depletion of CD4+ lymphocytes, resulting in a decrease of “helper” T cells,[6] with symptoms emerging when levels fall below 200/µL. Nowadays, the rate of clinical progression can be predicted by analyzing plasma levels of HIV-1 RNA.(7-13) Patients with chronic HIV infection usually exhibit prodromal symptoms, developing what is known as the AIDS-related complex (ARC), which includes nontender lymph node enlargement, fever, night sweats, progressive weight loss, and diarrhea for weeks or months. All HIV-seropositive patients will progress to AIDS, but a small minority, called “long-term non-progressors” or “elite controllers,” can naturally suppress their infections (without any treatment), maintaining nearly undetectable levels of plasma HIV. This disease is highly variable in its clinical presentation, ranging from asymptomatic cases to various chronic or recurring signs and symptoms, and a wide variety of opportunistic conditions. Early or primary infection is called acute retroviral syndrome, which is characterized by fever, pharyngitis, skin rash, arthralgias, mucosal ulcerations, and neurologic manifestations.[14] Retinal vasculopathy with cotton-wool spots and retinal hemorrhages are the most common ocular lesions of HIV-related microangiopathy. When CD4-positive T lymphocytes drop below 200 c/μl, there is a higher risk of vulnerability to systemic opportunistic infections, including concomitant retinopathy for cytomegalovirus (CMV) or herpetic, toxoplasmic, or syphilitic infection. A typically mild iritis may occur in association with viral retinitis, particularly CMV retinitis. The latter can be the initial sign of systemic CMV tissue infection in these patients, particularly in advanced immunosuppression condition (CD4+ count less than 50/µL). Therefore, it is reasonable to use the CD4 cell count as a threshold below which to screen patients for the higher risk for developing CMV retinitis with CD4 cell count below 50/µL. Retinal detachment is a common cause of vision loss in patients with CMV retinitis, associated with healed or active CMV retinitis due to tears in the necrotic retina. CMV retinitis may be treated systemically or intravitreally. Systemic treatment, however, is associated with a lower spread of CMV retinitis from one eye to the other (15), compared to local treatment, including the sustained-release ganciclovir implant. In AIDS, precursor lesions of retinitis are cotton-wool spots near the optic disc, that are the most common ocular lesions, occurring in 25% to 50% of patients (16) and up to 92%, (17), and they appear to be related to microinfarcts of the retinal nerve fiber layer.
Other ocular signs may include non-infectious retinopathies (18) and Kaposi’s conjunctival sarcoma, followed less frequently by herpes zoster ophthalmicus, (19,20) choroidal P. carinii infection, herpes zoster retinitis (acute retinal necrosis [ARN] and progressive outer retinal necrosis), and cryptococcal choroiditis. Non-infectious retinopathy typically presents cotton-wool spots and retinal hemorrhages; microvascular abnormalities usually do not progress. On the contrary, HIV-related neuroretinopathy involving the optic nerve may cause
color vision disturbances on contrast sensitivity testing. [21]
Other frequently involved pathogens include Candida albicans, Pneumocystis jiroveci, Mycobacterium tuberculosis, Mycobacterium avium and Cryptosporidium spp.(3,22). Choroidal infections by Coccidioides, Cryptococcus, Pneumocystis, M. tuberculosis, Aspergillus, Toxoplasma, Histoplasma, and M. avium-intracellulare are usually associated with systemic infection, although cryptococcal choroiditis has been described in the absence of systemic infection (e.g.,meningitis).(23-25). Histoplasma capsulatum chorioretinitis and endophthalmitis, Paracoccidioidomycosis brasiliensis chorioretinitis,(26) keratitis sicca, cranial nerve paralysis, Roth’s spots, papilledema, perivasculitis, and fungal corneal ulcers are very rare but have been reported. (27)
Microvasculature impairment is very common in AIDS, with high variability and features similar to diabetes mellitus, including microaneurysms, telangiectasias, focal areas of non-perfusion, and capillary loss(17), likely due to blood vessels thickening and precapillary arteriolar closure. In some cases, branch or central retinal vein or artery occlusions and ischemic maculopathy have been reported in HIV-infected patients without infectious retinitis. Retinal hemorrhages may be observed in association with CMV retinitis and cotton-wool spots or as an isolated finding. Occasionally, hemorrhages may appear as Roth spots (with a central white area). (17,29) It is known that the pattern of retinal hemorrhages can continuously change over time due to AIDS itself.(4)
On OCTA examination, a correlation has been found between the number of cotton-wool spots and decreased cerebral blood flow in symptomatic HIV infection.(30) Microvascular abnormalities on OCTA can also be detected even without evidence of retinal disease. (31) On FA, possible results of retinal non-perfusion can be observed. On OCT scanning, a “hyper-reflective sign”(32) may be seen, followed by thinning of the inner retina years after their disappearance (33) due to the loss of retinal nerve fibers and optic nerve fiber layer. (32,34)
It is estimated that HIV neuroretinal disorders occur in 16% to 50% of patients 20 years after an AIDS diagnosis. (35,36)
In HIV-infected patients, acute retinal necrosis of infectious herpetic nature can occur as a fulminant panuveitis with confluent and well-demarcated areas of retinitis which have rapid progression and worsening, concomitant anterior uveitis, retinal and choroidal occlusive vasculitis, vitritis, and papillitis. Progressive and rapid outer retinal necrosis is another possible variant of herpetic retinitis in these types of patients, almost always caused by varicella-zoster virus, characterized by early patchy multifocal deep outer retinal lesions and late diffuse thickening of the retina without vessel inflammation.
Over the years the management of HIV disease has evolved and changed rapidly, with the development of over 30 drugs. Multiple mechanisms have been proposed including binding to receptors for the entry into the host cell, reverse transcription of HIV RNA into proviral DNA, and integration of the proviral DNA into the host cell genome, as well as the maturation of HIV after budding through the action of HIV protease.(37) However, a high level of resistance to all available treatments can develop due to poor patient compliance to long-term therapy and for possible cross-resistance to drugs within a class.(38-41) If a treatment regimen fails, the next combination of drugs is less likely to be fully effective in suppressing HIV replication (Guidelines for the Use of Antiretroviral Agents in HIV-1-Infected Adults and Adolescents,” available on the NIH website). Although Highly Active AntiRetroviral Therapy (HAART) often reduces plasma HIV-1 viremia to undetectable levels, the latent viral reservoir of resting CD4 lymphocytes persists for years and reappears in the blood as soon as the therapy is stopped. (42) Many other antiretroviral agents are currently in preclinical and clinical studies. However, no currently available drug is capable of completely eradicating latent HIV infection. When used in combination, they usually decrease viral replication, improve immunological status, reduce the risk of infectious complications, and extend life expectancy.
Cytomegalovirus (CMV) is a major cause of morbidity and mortality in AIDS infection, mainly affecting those with decliningCD4+ counts. It impacts 15 to 40% of patients with AIDS, and its incidence has decreased since the introduction of HAART therapy. (43-46)
CMV retinitis is one of the most common forms of CMV infection in the eye, with an incidence rate of 0.36/100 person-years in individuals with AIDS. It has been reported in young children with a high absolute CD4 count (5-7%) (47-50)
CMV is a neutropenic virus that targets neural tissues. In fact, when CMV affects AIDS patients, retinal necrosis may occur, characterized with typical cytomegaly and inflammatory cells on histological findings.
Patients with diagnosis of CMV may present with symptoms such as fever, arthralgia, pneumonitis, or leukopenia, retinitis, or hepatitis.
Ocular infection can involve various structures. In the anterior segment, the most typical presentation is a fine, stellate keratic precipitate on the corneal endothelium. (51) Posteriorly, retinal vascular non-perfusion and retinal neovascularization, and choroiditis has been reported (52), although choroidal involvement is less typical, and the involvement of the vascular endothelium involvement remains unclear. The most common presentation remains CMV retinitis, which carries a severe risk of vision loss, thus it should be promptly identified and treated. (53-55)
CMV causes progressive retinitis in the posterior pole, affecting the eye either unilaterally or bilaterally. Retina lesions appear as non-contiguous patches that test positive with immunofluorescence immunoperoxidase staining, as well as with DNA hybridization techniques. (56,57) . The typical presentation is a white intraretinal lesion with infiltrate, necrosis, and often retinal hemorrhage within or along the necrotic area. When these lesions occur in the periphery, they tend to be clearer and hemorrhages may be absent.
In children, posterior pole involvement is more frequently observed. (58-61) If left untreated, retinitis may progress to form an avascular atrophic area with underlying RPE hyperplasia or atrophy. (62-64) Once healed, CMV retinitis leads to a glial scar without opacity. Intraretinal edema, attenuated vessels, perivascular sheathing, and exudative retinal detachment may be present (65). Vitreitis and anterior uveitis are also possible manifestations. As the retina undergoes progressive destruction, optic nerve atrophy may also occur.
Patients may initially report the presence of floaters with or without visual field defects, which could indicate early peripheral involvement. Retinal detachment may also develop. Widefield fundus photography is extremely useful for diagnosis and follow-up, since it appears to be a more sensitive indicator of progression than indirect ophthalmoscopy (66,67). On FA, CMV lesions show areas of non-perfusion and blockage, along with staining and leakage of fluorescein from damaged retinal vessels. Re-opacification of the border of the lesion may be a sign of reactivation.
OCTA has shown a decrease in the density of the superficial and deep retinal capillary plexus vessels in the affected eye compared to the healthy one, suggesting that macular microvascular abnormalities may precede clinically visible CMV lesions.(68)
Differential diagnosis can be made with other causes of retinitis, as herpes simplex retinitis, Behçet’s disease, syphilis, and acute retinal necrosis (69-72)
Treatment of CMV retinitis is mandatory. Studies have demonstrated that CMV retinitis is progressive in patients with AIDS (56,75-77)
Treatment options include systemic, local (intravitreal), or combination of both. (80-81) Ganciclovir, valganciclovir, cidofovir, and Foscarnet are drugs approved by the US Food and Drug Administration (FDA).


The advantage of a systemic treatment is its ability to prevent the spread of CMV infection to the other eye (82,83). However, it may be associated with side effects, such as GI disease, with colitis and esophagitis being the most common manifestations. (84)
Intravenous therapy with Gangiclovir, a nucleoside analog of 2-deoxyguanosine similar to acyclovir (85), is also available and requires an induction phase followed by a maintenance phase to prevent recurrence in the diagnosis of CMV retinitis. Side effects of Ganciclovir include granulocytopenia, neurological dysfunction, abnormal liver function tests, and thrombocytopenia. Although generally reversible, the most severe toxic effect is granulocytopenia, (fewer than 500 neutrophils per microliter), which can be present in up to one-third of patients (86) . Ganciclovir may also be used orally.
Valganciclovir is an alternative treatment. Studies have demonstrated that oral Valganciclovir, the valine ester of ganciclovir, is highly effective against CMV retinitis without the complications with IV administration.(87,88)
Foscarnet and Cidofovir are also available treatments for CMV retinitis. Foscarnet is active against HIV, thus, making it seemingly ideal for treating HIV-infected patients. However, it is only available for IV administration, and it is associated with significant toxicity. (89,90)
Intravitreal Cidofovir is an effective treatment for patients with progressive peripheral retinitis due to previously untreated CMV retinitis and AIDS, providing long-term suppression of CMV retinitis. (91,92)
Systemic therapy typically involves an induction phase with oral Valganciclovir 900 mg twice daily for 3 weeks, followed by a maintenance phase with 900 mg daily. IV ganciclovir can be used if a patient has a contraindication to oral treatment, such as malabsorption. Due to toxicity problem, local therapy may be an appropriate solution, with the possibility of intravitreal injections of Ganciclovir, Foscarnet, or Cidofovir. (93)
Syphilis is a disease caused by the infection with Treponema pallidum. Historically, Syphilis has been found in human populations with poor hygiene and low quality of life.
Data from the USA have shown that the rates of primary and secondary Syphilis are the highest since 1991. The disease is most common among young males, especially among men who have sex with men (MSM). (94-96)
Treponema pallidum is a spirochete that triggers both local and systemic responses once it enters the body, and that invades the tissues by spreading through the blood and lymphatic system. As a result, the disease manifests in the iris, ciliary body and choroid.
Ocular manifestations of syphilis usually appear shortly after the second stage of the disease. (97-98)
Uveitis is the most common ocular manifestation of Syphilis, occurring in 0.7 to 16.4% of cases, mostly in patients with a co-diagnosis of HIV.(96,99) In these patients, the primary ocular presentation of syphilis is posterior uveitis and panuveitis (96)
In the anterior segment, syphilis can cause interstitial keratic precipitates and iritis, presenting as either non-granulomatous or granulomatous inflammation, characterized by microscopic granulomatous infiltration, both diffuse and focal. Dilated iris capillaries may also be present, as a result of obliterative endarteritis.
Posteriorly, syphilitic infection manifestations can include vitreitis, vasculitis, papillitis, periphlebitis, uveal effusion, exudative retinal detachment, retinal necrosis, neuroretinitis, and the formation of subretinal neovascular membranes. (96-101)
Diagnosis is typically clinical, based on a high level of suspicion. On fundoscopic examination, acute posterior placoid syphilitic chorioretinitis usually appears in the macular or juxtapapillary region. (102,103) It presents a yellow or gray placoid lesion with central atrophy, without evidence of fluid or hemorrhage. Dense vitreitis or diffuse creamy retinitis with punctate retinal precipitates may be present, particularly in HIV-positive patients with posterior uveitis or panuveitis (96,104,105)
In FA, ocular syphilis shows early hypofluorescence and late staining of the lesion with leopard-spot-like hypofluorescence.
OCTA can detect non-perfused and neovascular areas. OCTA is occasionally better at detecting vascular abnormalities, retinal capillary changes, and neovascular formation compared to FA. (106)
In any case, the gold standard remains the visualization of the organism in exudates or lesion tissues via dark-field microscopy with immunofluorescent staining (107). Serological tests, including nontreponemal, treponemal tests, (Venereal Disease Research Laboratory (VDRL) and rapid plasma reagin (RPR) tests, are frequently used in ophthalmology, though these tests are more suitable for screening and therapy follow-up.
Treponemal tests, such as fluorescent treponemal antibody absorption tests (FTA-ABS) and the microhemagglutination test for T. pallidum (MHA-TP) are more specific than non-treponemal tests, although they are more expensive.
Enzyme immunoassays (EIAs) and chemiluminescent assays (CIAs), and other new treponemal tests can also be appropriate. Other possible tests are polymerase chain reaction (PCR) assays and point-of-care tests (POCTs). (97)
Differential diagnosis should include other conditions affecting the choroid and retina such as toxoplasmosis, rubella, and CMV. Moreover, it is important to consider that an ocular syphilis diagnosis might reveal an underlying, previously unknown condition that should be investigated. (108)
The management of syphilis has completely changed since the introduction of Penicillin G,
which is now the preferred treatment for all stages of the disease, with varying dosage depending on the clinical presentation and severity. Sexual partners should also be treated. (109) Ocular manifestation of Syphilis can be treated as a form of neurosyphilis, thus crystalline aqueous penicillin G intravenous is indicated (97). Moreover, once the ocular condition is identified, a cerebrospinal fluid (CSF) examination is recommended, and therapy should be of sufficient dose and duration to treat neurosyphilis. (109) Effective therapy is defined by clinical improvement and seroconversion and is determined by early diagnosis and prompt treatment. After treating the infection, corticosteroid therapy may be used to address residual ocular inflammation. Topical corticosteroids are ideal for anterior uveitis and interstitial keratitis, while systemic corticosteroids may be required for residual symptoms of scleritis, posterior uveitis, or optic neuritis. (97)
If well treated, this condition usually leads to complete visual acuity recovery. If left untreated, chronic vitreitis, optic atrophy, secondary glaucoma resulting from chronic uveitis, and retinal necrosis can occur.
Tuberculosis (TB) is the clinical condition resulting from infection by the tuberculous mycobacterium. It is considered as one of the main causes of death worldwide. (110)
The term ocular TB includes both the tuberculous and non- tuberculous mycobacterial disease.(111,112) TB is the most common opportunistic infection in HIV-positive patients in developing countries. HIV and TB tend to exacerbate each other’s condition. In fact, people living with HIV are 20 to 30 times more likely to develop TB than HIV-negative patients.(113) TB mostly affects adult males; in fact, in 2018, 57% of cases involved adult males, 32% adult females and 11% children. (110)
The physiopathology is due to an aerobic rod-shaped bacterium, Mycobacterium tuberculosis, that infects humans through droplets. However, the disease is not always apparent: in fact, the immune system is able to contain it. Otherwise, within 3-8 weeks, the disease spreads locally and systemically, affecting the lungs and various organs, thus causing extrapulmonary TB. (114)
The extrapulmonary form of TB can also involve the eye. Three classic forms of ocular TB have been identified. The first case involves direct ocular infection of the conjunctiva, sclera, cornea or adnexa. The second form is related to a hypersensitivity reaction, causing episcleritis and occlusive hemorrhagic retinal vasculitis. The last form is due to the spread of infection from pulmonary and extrapulmonary sites.
Tubercular uveitis is one of the main forms of infectious uveitis in tropical countries. (115,116,117) It presents as anterior, posterior or panuveitis, either unilateral or bilateral, with a chronic course. Although it is predominantly granulomatous, It can also be non-granulomatous. (118,119)
Due to the particular affinity of M. tuberculosis for oxygenated tissues, the choroid is frequently affected by TB. Several manifestations of infection may occur in the choroid. A pathognomonic manifestation is multifocal chorioretinitis, with pigmented scars and exudative hemorrhagic retinal periphlebitis. Serpiginous like choroiditis (SLC) is also a frequent presentation, appearing as a scattered, highly pigmented multifocal lesion with vitreous cells. (115,116,120) Other manifestations include subretinal abscesses, solitary choroidal granuloma, pigmented chorioretinal scars along the vessels, and optic disc granulomas.
The presence of a relevant tuberculoma with exudative retinal detachment and exudates requires differential diagnosis with choroidal neoformation. (121,122)
Once clinical suspicion arises, clinical and laboratory evaluations are necessary. In patients
with choroidal tubercles, these may show early hypofluorescence and late hyperfluorescence on FA. Moreover, there may be staining of the vascular, vascular leakage, disc staining and pooling in the area of exudative detachment. At OCTA, these patients have shown reversible CC flow deficits, with complete visual recovery. (123) However, a definitive diagnosis is only obtained by isolating mycobacteria from ocular structures.
The presence of any of the following signs supports the diagnosis of tuberculous uveitis: choroidal granuloma; broad-based posterior synechiae; retinal vasculitis with or without choroiditis; or serpiginous-like choroiditis with a positive tuberculin skin test, QuantiFERON TB Gold test, or any other relevant tests, such as a chest radiography and computed tomography.
Resolution of the condition following anti-tuberculosis treatment further supports the diagnosis. (114,124)
The differential diagnosis should include other retinal and choroidal conditions characterized by granulomatous uveitis, such as herpes simplex or Varicella zoster infection, sarcoidosis, and syphilis. (115,116,125)
TB infection requires early specific anti-tuberculosis treatment to regress the infection within a month. (126,127). Systemic treatment is also effective in resolving ocular infection too, and reduces uveitis recurrences.(128) In ocular TB, steroids may also be useful in reducing inflammation; however, the dosage and duration of corticosteroid treatment have not yet been defined. (129)
Acute retinal necrosis (ARN) syndrome is a fulminant necrotizing retinitis associated with viruses, primarily members of the Herpesviridae family. It is usually characterized by unilateral panuveitis, vitritis, retinal arteritis, and a high rate of retinal detachment, typically occurring in immunocompetent hosts [130]
ARN is a rare disease, and its precise incidence is unknown. Two surveys conducted in the UK reported an incidence of 1 case per 1.6-2.0 million population per year [131]. The incidence is almost equal between males and females, with cases ranging from the first decade of life to old age.
Specific human leukocyte antigen (HLA) haplotypes, such as the HLA-DQw7, HLA-Bw62 and HLA- DR4 in American Caucasian populations [132] and HLA-Aw33, HLA-B44 and HLA-DRw6 in Japanese patients [133], are associated with a higher relative risk of developing ARN syndrome. The varicella-zoster virus (VZV) is identified as the most common etiology of ARN: some studies have identified VZV-DNA in intraocular fluids via PCR in up to two-thirds of cases [134]. Herpes simplex virus (HSV) type 1 is also a frequent etiological agent of ARN and is associated with a higher risk of meningitis or encephalitis. HSV-related viral encephalitis, often linked with mutations along the TLR3 pathway leading to reduced IFN-gamma production [135], is considered as a risk factor for subsequent ARN syndrome, usually occurring within 2 years after encephalitis.
ARN caused by HSV type 2 tends to affect younger individuals (with an average of 21 years) [136] . Other rare viruses, such as CMV, Epstein-Barr virus (EBV) and Human Herpesvirus 6 (HHV-6), can present with ARN-like features [137,138]. Is unclear if other viruses, such as adenovirus and pseudorabies virus, detected via PCR, are incidental contaminants or true causal agents of ARN [138,140]
Immunosuppression, whether due to systemic or local medications, also increases the risk of ARN syndrome. There are several reports of ARN following treatments such as natalizumab for multiple sclerosis, epidural steroid injection, intraocular or periocular steroid injections, and
intravitreal implants of dexamethasone or fluocinolone acetonide [141,143]
Live attenuated vaccines for varicella zoster and influenza can still potentially cause ARN when administered to an immunocompromised host, and should therefore be avoided in such patients [144]
The viruses may spread either through bloodstream or via bilateral neural pathways, with retrograde axonal transport suggested in animal models, leading to early multifocal and deep retinitis [145]
The pathogenesis of retinal necrosis in ARN is multifactorial, involving direct viral cytotoxicity on retinal cells, immune complex-mediated obliterative arteritis, and T-cell mediated inflammation. Inflammatory spread into the vitreous has also been described. The initial symptoms of ARN include sudden visual loss, periorbital pain, eye redness, and photophobia [146]. Ophthalmoscopy may detect episcleritis, scleritis, keratitis (with unilateral ARN reported following HSV keratitis) [147], and mutton-fat keratic precipitates, and granulomatous or nongranulomatous anterior uveitis.
Indirect ophthalmoscopy will reveal multifocal full-thickness retinitis with “yellow-white lesions in the peripheral retina”, which are considered the hallmark of ARN, even though they appear in only 86% of patients in the early stage [148]. These lesions rapidly progress, becoming concentrically confluent, and spreading towards the posterior pole, although the macula is often spared. Active occlusive choroiditis and retinal vasculitis with perivascular hemorrhages, sheathing and terminal obliteration of arterioles are present The active retinitis phase usually lasts from 4 to 6 weeks [149,150]
The peripheral lesions pigment first at the posterior margins as a sign of resolution, leaving a scalloped appearance. Retinal breaks are usually located at the junction between normal and necrotic retina. Three out of four affected eyes develop rhegmatogenous retinal detachment, generally within 1 or 2 months from the onset of the disease, although it may occur as an early complication [151,152] Vitreitis can lead to preretinal fibrosis and proliferative vitreoretinopathy [153] adding a tractional component to the retinal detachment. The terminal stage of the disease is characterized by retinal atrophy, scleritis, anterior uveitis and ocular hypotony. Furthermore, the optic nerve can be involved, with significant optic disc edema, papillitis, optic neuritis, or neuropathy. Progression through the optic chiasm from one eye to the other can lead to meningoencephalitis.
ARN is bilateral in 36% of untreated patients. Usually, the second eye develops ARN within 6 weeks of the onset in the first eye [151,154], but it may be affected many decades after, despite treatment in the first eye. Cerebrospinal fluid pleocytosis has been described. Cutaneous manifestations of varicella-zoster infection may occur before, after, or simultaneously of ARN [155]
ARN must be differentiated from the Progressive Outer Retinal Necrosis (PORN), a severe, rapidly progressing multifocal necrotizing retinitis in immunocompromised hosts, such as HIV-infected patients. VZV is the primary infectious agent. PORN manifests as outer retinal whitening in the posterior pole, then involves the entire retina, leading to necrosis and atrophy. There is an absence of inflammation in the vitreous or anterior chamber or signs of active vasculitis. Retinal detachment can occur in up to 70% of patients. A peculiar feature is the perivascular clearing of the retinal opacification [156]
In 1994, the American Uveitis Society refined the diagnostic criteria for ARN, dividing them into mandatory and supporting criteria. According to these, the diagnosis of ARN is based solely on clinical findings.
The mandatory clinical criteria are: 1) one or more foci of retinal necrosis with discrete borders, located in peripheral retina, 2) rapid progression of the disease in the absence of thera-
py, 3) circumferential spread of the disease, 4) evidence of occlusive vasculopathy and arteriolar involvement, 5) a prominent inflammatory reaction in the vitreous and anterior chamber. The supporting clinical criteria include optic neuropathy/atrophy, scleritis and pain [157] . In 2021, the Standardization of Uveitis Nomenclature (SUN) Working Group defined key criteria for ARN as (1) peripheral necrotizing retinitis (2) a positive PCR test from an intraocular fluid sample for HSV or VZV, or (3) a characteristic clinical presentation with circumferential or confluent retinitis, retinal vascular sheathing and/or occlusion, and more than minimal vitritis [158]
Aqueous or vitreous samples are analyzed to determine viral etiologies, but if toxoplasmosis is a possible diagnosis, vitreous biopsy is preferable. PCR is considered the most sensitive and specific method for detecting viruses. Endoretinal biopsy from the transition zone between normal and necrotic retina may be appropriate when PCR results are negative, but clinical suspicion remains high [159]
OCT can be useful when the macula is involved, though this is rare. Hyperreflectivity and thickening of the inner plexiform layer are early changes due to edema of the inner retinal layers caused by occlusive vasculopathy of the arteries, followed by involvement of all retinal layers corresponding to the white-yellow lesion. As retinitis progresses, the disorganization of all retinal layers and hyporeflective spaces suggest retinal tissue loss.[160] The schisis-like separation of the inner and outer retinal layers may indicate vitreous traction [161]
Anecdotal studies have compared FA and ICGA in patients with ARN. While FA showed widespread dye leakage from all retinal veins, ICGA identified only the retinal vessels with the most significant vascular damage, as well as choroidal vascular lesions [162] .
On OCTA, macular vascular density decreases in both the superficial and deep vascular plexuses supplied by the capillary branches of vessels surrounded by necrotizing retinal lesions. The choriocapillaris is not affected because acute necrosis is localized to the retina. Treatment can improve vascular flow and reduce retinal damage [163]
The main differential diagnosis for ARN includes toxoplasmosis, CMV retinitis, vasculitis, syphilitic retinitis and large cell lymphoma [164]
If left untreated, ARN generally has a poor prognosis, especially in eyes infected by VZV rather than HSV. Although no precise guidelines exist, the most commonly used regime involves an induction phase with intravenous Acyclovir 500 mg/m2 or 10 mg/kg every 8 hours for 5-10 days, followed by oral antivirals such as Acyclovir, Valacyclovir, Famciclovir or Valganciclovir. Acyclovir (800 mg orally five times daily) is highly effective against VZV, HSV types 1 and 2 and EBV, but less effective against CMV. It is administered for 6 weeks after disease onset, and for a longer period in immunocompromised patients. Prodrugs such as Valacyclovir (1 g orally three times daily), Famciclovir (500 mg orally three times daily) or Valganciclovir (900 mg two times daily) have high systemic absorption and are used for prophylaxis against second eye involvement [165-168]. With proper management, bilateral ARN has an occurrence rate of ~3%. The duration of maintenance therapy is controversial, usually lasting at least 6 months or longer [169]
Lifetime maintenance therapy may be necessary, especially in immunosuppressed patients with AIDS .
In cases resistant to Acyclovir, early administration of intravitreal antivirals (ganciclovir or foscarnet) can be useful and provides vitreous sampling, allowing for etiology identification based on PCR [170]
Although steroids are generally contraindicated in immunosuppressed patients, they have been administered in immunocompetent patients to reduce vitreous inflammation. Prophylactic laser therapy and prophylactic vitrectomy have been proposed to reduce the rate
of retinal detachment in patients with ARN, but the results are controversial [171,172]
Retinal tears and proliferative retinopathy that lead to complicated combined tractional–rhegmatogenous retinal detachment are challenging to manage. Delayed onset of retinal detachment (median of 30 days) is associated with better outcomes compared with earlier onset (median of 8 days). The rate of recurrent retinal detachment is approximately 46% [134,173,174]
Anticoagulants, along with high-dose oral corticosteroids, may be used for optic nerve dysfunction caused by ischemia from swollen vascular endothelial cells, thrombotic arteriolar occlusion, and optic nerve infiltration by inflammatory cells [175]
Ocular toxoplasmosis (OT) is a retinitis –almost always accompanied by vitreoretinal complications such as vitritis and choroiditis– caused by intraocular infection with Toxoplasma gondii that can lead to blindness. [176, 177]
The prevalence of OT differs worldwide: in the United States, it is not well established but ranges from 0.6% to 2% (an estimated 21,000 individuals annually). In South America, the infection is at least 10-times more common than in the United States, and in Brazil the prevalence ranges from 10% to 17.7%, where OT causes 40% of the posterior uveitis cases versus 25% in the US. [178,179,180,181]
Serologic evidence of a previous toxoplasma infection is present in 20%–70% of individuals in different countries, although a clear correlation between seroprevalence and the frequency of ocular disease has not been demonstrated [182]
T. gondii is an obligate intracellular protozoan parasite characterized by a life cycle that includes both sexual and asexual reproduction. The sexual cycle occurs exclusively in felines (the definitive hosts), which release a large number of infectious oocysts in their feces, contaminating food and the environment.
Organ transplants, blood transfusion, and water can transmit ocular toxoplasmosis [183,184]
Once ingested by intermediate hosts, the oocysts mature into tachyzoites which, under the pressure of the immune response, form tissue cysts, called bradyzoites. These are very resistant and can remain dormant in the host (retina, CNS, muscle tissue) without causing tissue damage for many years [185]. For unknown reasons, the cyst may eventually rupture, leading to the reactivation of acute and recurrent ocular disease.
OT is characterized by recurrent episodes of necrotizing retinochoroiditis: new lesions are usually focal and intensely white, histologically characterized by foci of granulomatous retinochoroidal inflammation and coagulative necrosis of the retina due to the proliferation of live organisms emerging from tissue cysts and/or inflammatory reaction triggered by autoimmune mechanisms [186,187]. Typically, hyperpigmented scars from old, inactive lesions are present, and recurrent lesions occur at the sharply demarcated edge of the healed scar as a satellite lesion [188]. Large, old lesions may have a white atrophic center due to the underlying sclera, without any retinal and choroidal elements above [189]. There is no difference between lesions resulting from congenital or acquired infections, although a relative predilection for the posterior pole of the eye characterizes congenital infections [176] Typically, toxoplasmic retinochoroiditis is a self-limiting disease. Untreated lesions generally begin to heal after 1 or 2 months, although the timeline can vary [190]. In immunosuppressed patients, the lesions tend to be widespread and often active in both eyes [191]
Occasionally, retinal vasculitis with vascular sheathing and hemorrhages develops in response to reactions between circulating antibodies and local T. gondii antigens [192]

Multicolor widefield fundus image (A) showing necrotizing retinochoroiditis in the macular area in ocular toxoplasmosis; spectral domain optical coherence tomography (SD-OCT) revealing vitreous cells, increased reflectivity from the inner retinal layer, retinal and choroidal thickening with choroidal shadowing and subretinal neural detachment (B); OCT angiography showing ischemia in the superficial vascular complex (C) and the deep retinal vascular complex (D).
Inflammatory changes can be widespread in the eye: there is a severe inflammatory reaction in the vitreous with the classic “headlight in the fog” appearance. Anterior uveitis may be present, characterized by inflammatory cells in the aqueous humor, medium-sized keratic precipitates, and posterior synechiae [193]. Sometimes, in recently acquired infections, OT presents as vitritis or anterior uveitis without retinochoroiditis. Fuchs’ heterochromic cyclitis can be present.
The most common clinical signs of active ocular toxoplasmosis are blurring or loss of vision and floaters.
Central vision will be lost if lesions affect the fovea, the maculopapillary bundle, or the optic disc.
Complications include vitreous hemorrhage and epiretinal membrane formation, vascular occlusion, macular edema and retinal neovascularization. Rhegmatogenous and tractional retinal detachments, as well as secondary glaucoma and cataract, may occur [194] .
Diagnosis is clinical and relies on ophthalmoscopy and indirect ophthalmoscopy.
Serological tests should only be used to confirm past exposure to T. gondii, not for diagnosis: serum IgG antibodies can persist at high titers for years and there is a high prevalence of such antibodies in the general population. Since active retinal lesions are usually foci of recurrent disease, serum IgG titers may be low and IgM may be absent. The serological determination of IgA antibodies may help determine the timing of the primary infection because they remain in the serum for a shorter period [195]
On SD-OCT, active toxoplasmic retinochoroiditis presents with thickened and hyperreflective retina, thickening and hyperreflectivity of the choroid, hyperreflective vitreous dots and deposits, and thickening of the posterior hyaloid. Retinal hyporeflectivity, which suggests liquefactive necrosis, predicts poor visual outcome.
Adjacent disorganization of the retinal layers is often observed. Over time, the retina thickens and becomes less hyperreflective, but does not return to a normal appearance, and there is thickening of the retinal pigment epithelium with choroidal hyporeflectivity, or epithelial atrophy with choroidal hyperreflectivity [178]
In active lesions, OCTA has shown extensive and well-defined areas of intense hyposignal and perifoveal capillary arcade disruption in the parafoveal superficial capillary plexus and less extensive hyposignal in the parafoveal deep capillary plexus. Signs of reduced deep capillary density and disorganization were also seen in the choriocapillaris and Sattler’s layers. In inactive lesions, OCTA demonstrated a homogenous and equally attenuated grayish hyposignal of superficial and deep capillary plexus and a partial restoration of the nonperfused choroidal areas [196]
The FA results included early hypofluorescence and intense late hypofluorescence with blurred margins of the retinochoroidal lesion in all active lesions. Occasionally, FA showed hyperfluorescence of the optic nerve and leakage from vessels and/or vascular and neuroretinitis. In eyes with inactive lesions, scar hyperpigmentation appeared hypofluorescent, while atrophic areas appeared hyperfluorescent on FA.
ICGA revealed hypofluorescence of both active and inactive lesions in all phases of the angiogram, and multiple hypofluorescent satellite dark dots around the active retinochoroiditis lesions, which are not always detected on fundus examination or FA [197]
FAF results for active lesions showed hyperautofluorescent spots within the retina around the active foci. The spots matched the satellite dark dots observed on ICGA and are likely related to the RPE or inflammatory lesions of the outer retinal [198]
The identification of T. gondii DNA through polymerase chain reaction (PCR) in the aqueous humor and vitreous, as well as in ocular tissue sections, is possible even when microorganisms are not identified in histopathologic examination. However, the procedures required to obtain samples are associated with significant risks that prevent their routine use [199,200] .
Tissue cysts cannot be eliminated, and chronic infection cannot be prevented. The most commonly used drug combination is pyrimethamine, sulfadiazine and corticosteroids. Steroids decrease the inflammation and therefore help achieve better visual outcomes, but should not be used without anti-toxoplasmic drugs in order to avoid worsening of the infection [201,202]
The trimethoprim–sulfamethoxazole (TMP–SMX) combination is probably equally effective and has fewer side effects and better patient compliance. It may be considered for high-risk patients (those with frequent and severe recurrences and those with retinochoroidal scars adjacent to the fovea) as an intermittent long-term treatment to reduce the rate of recurrent toxoplasmic retinochoroiditis. However, this treatment regimen is only effective when the patient adheres to it. TMP– SMX is associated with a higher risk of severe allergic reactions due to the prolonged duration of sulfamethoxazole. The duration of treatment depends on the individual clinical picture [203,204]
Local treatment with intravitreal injections of clindamycin and dexamethasone, without concomitant systemic therapy, is an option during pregnancy or for patients with allergies or inadequate responses to oral medications [205]
Local drops are used when anterior uveitis is present.
Cataract surgery secondary to severe inflammation should be performed after 3 months of uveitis inactivity to restore vision and allow fundus examination [206]
Vitreous opacity usually improves spontaneously up to 6 months after the active lesion but persistent vitreous opacity, epiretinal membranes, and retinal detachment may require retinal surgery.
The incidence of endogenous endophthalmitis is increasing and highly variable due to different potential risk factors (207,208), particularly related to prematurity or a compromised immune system in individuals undergoing treatment with antineoplastic or immunomodulating agents that increase susceptibility to infections.(207-209) Furthermore, new families of broad-spectrum antimicrobial drug are being developed, leading to a consequent reduction in immune system defenses. (207-209) In the United States, the most common organisms are Gram-positive bacteria (45%), fungi (34% predominantly Candida spp.), and Gram-negative (3%). Candida albicans is the main cause of endogenous fungal endophthalmitis.(210-211)
It may be found as a commensal organism in the gastrointestinal tract and mucous membranes of healthy individuals.(212) The organism typically has low virulence in healthy individuals.(213) The mortality rate among patients with candidemia and endogenous Candida endophthalmitis is of 77% and is very common in intravenous drug users. (8,9) Other Candida species include C. tropicalis, C. parapsilosis, C. glabrata, C. guilliermondii, C. krusei, C. dubliniensis, and C. palmioleophila, with misdiagnosis occuring in 50% of cases (216,217)
On retinography, the most pathognomonic clinical sign of Candida endophthalmitis is one or more creamy yellow-white retinochoroidal lesions originating from the retinal pigment epithelium/choroidal layer, well-defined chorioretinal lesions usually less than 1 mm in diameter, frequently located in the posterior pole, with an overlying haze of inflammatory vitreous cells. Also, yellow or fluffy-white vitreous opacities with a “string of pearls” configuration or retinal hemorrhage with evidence of vasculitis can be observed. (218)
On OCT examination, macular chorioretinitis can be documented as a subretinal macular lesion, which usually shows a thinning and hyperreflective fibrosis after intravitreal treatment. Specifically, four types of OCT manifestations of retinal lesions have been identified: type 1 (subretinal macular lesions), type 2 (lesions located in the inner retinal layer), type 3 (lesions affecting full-thickness retina accompanied with macular edema), type 4 (lesions of the sub-inner limiting membrane). (219)
Treatment of such fungal endophthalmitis can be carried out with systemic antimicrobial agents, thanks to the high vascularization of the choroid and retina.(220) Pars plana vitrectomy combined with intravitreal antifungal injection can be a good option for patients who do not respond to intravitreal and systemic antifungal treatments alone.
Intravenous Amphotericin B is generally effective in treating infections caused by Candida, as well as Aspergillus, Blastomyces, Coccidioides, and other fungi.(221-224) Unfortunately, several toxic effects can occur, including renal failure, chills, fever, vomiting, nausea, diarrhea, dyspnea, malaise, anemia, arrhythmia, hypokalemia, and hearing loss. (222) The intravitreal penetration of systemic amphotericin B is relatively low, and although successful treatment of Candida endophthalmitis using only systemic amphotericin B has been reported, (223) this approach has a high treatment failure rate.(225) Generally, either a systemic agent with better intraocular penetration is chosen or a combined systemic and intravitreal treatment is used. The azoles family is an effective class of alternative antifungal drug, with newer triazoles (fluconazole, itraconazole, voriconazole, and posaconazole).(226) Voriconazole is a second-generation synthetic azole derived from fluconazole, highly effective both orally or intravenously against Candida species (including those resistant to fluconazole), (227) as well as Aspergillus and Cryptococcus.[228]
A variety of systemic and topical/intravitreal therapies can be associated with retinal changes and/or toxicity. In most cases, visual function loss is minimal and sometimes reversible after discontinuation of the drug.
Hydroxychloroquine, currently approved by the U.S. Food & Drug Administration (FDA) for malaria prophylaxis, has several off-label uses for long-term daily treatments, including for various inflammatory and oncologic conditions.
In daily users, hydroxychloroquine-related toxicity has been estimated at around 7.5%, with variations depending on duration and dose based on body weight, (229) approaching 1% after 5-7 years and/or a cumulative dose of 1,000 g, and reaching nearly 20% after 20 years of continuous use. (229-232) The concomitant use of tamoxifen has also been highlighted in the new guidelines as a risk factor for accelerated development of retinopathy. After discontinuation of treatment, early subtle macular changes and mf-ERG tests may return to normal. (233)
The exact mechanism of its toxicity is currently unknown, but various proposed mechanisms are related to disruption of lysosomal function in the RPE, which causes secondary degeneration of photoreceptors. Hydroxychloroquine has a very slow excretion from the body, accumulating in the plasma, red blood cells, and urine of patients after more than 5 years of assumption. (234-236)
Hydroxychloroquine can cause a characteristic pigmentary maculopathy, although it has a higher safety profile compared to chloroquine. The subtle macular pigment changes usually precede the development of classic bull’s-eye maculopathy. In more severe cases, peripheral pigment mottling with bone spicules, narrowed retinal vessels, and optic disc pallor can be observed, which can lead to blindness. (237,238) The appearance of the advanced stage is similar to that of end-stage retinitis pigmentosa.
Clinically paracentral scotoma can be the first manifestation of retinal toxicity. Visual acuity decreases when abnormalities in the retinal pigment epithelium (RPE) involve the central fovea. On OCT examination, perifoveal thinning or atrophy of the outer retinal layers with intense hyperscattering and discontinuity or attenuation of the ellipsoid zone band are typical features that can precede functional visual loss. At FAF, early RPE changes can be detected as a paracentral ring of hyperautofluorescence, with more advanced stages showing pericentral mottled hypoautofluorescence with hyperautofluorescence. Advanced stages may demonstrate a complete loss of pericentral FAF (239). Ultrawide-field FAF is particularly useful for detecting peripheral RPE changes. FA may reveal macular pigment deposits in advanced cases. It is debated whether the initial sites of toxicity are the retinal nerve fiber layer, the inner plexiform layer, and the ganglion cell layer, or structural changes in photoreceptors. On the other hand, RPE changes develop in more advanced stages. (240,241)
In OCTA, changes in the perfusion of vascular capillary plexuses and the choriocapillaris have been reported in patients who have been taking hydroxychloroquine for more than 5 years. (242,243) However, some authors did not find significant differences in vascular density parameters between treated patients and control groups (244)
Among electrofunctional tests, the multifocal-ERG (mf-ERG) is the most definitive test for detecting retinal toxicity and can show abnormalities in the early stages of toxicity (245). In longterm users, multiple patterns of abnormalities have been reported including paracentral loss, blunting or loss of the central peak, peripheral loss, and generalized loss.
The 2016 guidelines of the American Academy of Ophthalmology for toxicity screening recommend a baseline evaluation within the first year of starting therapy. After 5 years of con-
tinuous treatment, screening examinations should be conducted at least annually, while in high-risk patients, annual screening should begin before 5 years, with more frequent tests using Humphrey visual field (HVF) and SD-OCT automated tests. (230,246) After discontinuation of treatment, early subtle macular changes and mf-ERG testing modifications tend to return to normal.
An appropriate ophthalmologist’s consultation with the patient to discuss therapy benefits and risk of toxicity is crucial, highlighting the extreme importance of an accurate screening, which today still remains quite fragmented.
Tamoxifen is a common antiestrogen drug used for the treatment of estrogen-receptor-positive tumors, such as advanced breast carcinoma and for some estrogen-receptor-negative cancers, such as hepatocellular carcinoma. In the early stages, it can also be used as adjuvant treatment following surgical resection of cancer. Tamoxifen-related retinal toxicity has a prevalence ranging from 0.9% to 12.0%, and its mechanism remains unclear (247,248). It has been described as a characteristic crystalline maculopathy with yellow-white perifoveal intraretinal crystalline deposits that are products of axonal degeneration, and is associated with cystoid macular edema in severe cases. Punctate retinal pigmentary changes can rarely be detected (249). Optic neuropathy related to tamoxifen has also been reported(250). FA shows perifoveal crystalline deposits with petaloid leakage consistent with CME. En-face optical coherence tomography angiography (B) of the deep capillary plexus demonstrates increased cavitations of the temporal fovea. Depending on the severity of the retinopathy, FAF may be normal or show macular hypofluorescence with foveal hyperfluorescence (251). A decrease in visual acuity and color vision can occur. In fact, ERG tests may reveal a reduction in both photopic and scotopic a- and b-wave amplitudes (252). EOG tests may show a decreased Arden ratio (253) . OCT examination usually reveals hyperreflective punctate lesions primarily located in the inner retina, with disruption of the external limiting membrane, ellipsoid zone, and interdigitation zone with or without CME (251,253). Notably, OCT findings in patients undergoing lower-dose tamoxifen therapy may not show any macular edema but rather foveal pseudocysts or cavitations resembling those seen in macular telangiectasia type 2 (MacTel2) (254-256) Müller cell toxicity may be the underlying pathogenesis in both disorders (257). On OCTA imaging, vascular changes have been assessed, showing telangiectatic alterations in the deep capillary plexus similar to those observed in the early stages of MacTel2.(258) Symptoms usually begin after 2 to 3 years of treatment in patients receiving high doses.
References
1. Review of draft for revision of HIV infection classification system and expansion of AIDS surveillance case definition MMWR Morb Mortal Wkly Rep 1991;40: 787.
2. Revision of the CDC surveillance case definition for acquired immunodeficiency syndrome. Council of State and Territorial Epidemiologists; AIDS Program, Center for Infectious DiseasesMMWR Morb Mortal Wkly Rep Suppl. 1, 1987;36: 1S-15S.
3. CDC. HIV prevalence estimates MMWR Morb Mortal Wkly Rep 39, 2008;57: 1073-1076.
4. Freeman WR, Lerner CW, Mines JA, et al. A prospective study of the ophthalmologic findings in the acquired immune deficiency syndrome Am J Ophthalmol 1984;97: 133-142.
5. Jabs DA, Green R, Fox R, et al. Ocular manifestations of acquired immune deficiency
6. Fauci AS. Immunopathogenic mechanisms of HIV infection Ann Intern Med 1996;124: 654-663.
7. Coombs RW, Welles SL, Hooper C, et al. Association of plasma human immunodeficiency virus type 1 RNA level with risk of clinical progression in patients with advanced infection J Infect Dis 1996;174: 704-712.
8. Hughes MD, Johnson VA & Hirsch MS. Monitoring plasma HIV-1RNA levels in addition to CD4 lymphocyte count improves assessment of antiretroviral therapeutic response Ann Intern Med 1997;127: 929-938.
9. Mellors JW, Kingsley LA, Rinaldo Jr CR, et al. Quantitation of HIV-1 RNA in plasma predicts outcome after seroconversion Ann Intern Med 1995;122: 573-579.
10. Mellors JW, Rinaldo Jr CR, Gupta P, et al. Prognosis in HIV-1 infection predicted by the quantity of virus in plasma Science 1996;272: 1167-1170.
11. Mellors JW, Munoz A, Giorgi JV, et al. Plasma viral load and CD4 lymphocytes as prognostic markers of HIV-1 infection Ann Intern Med 1997;126: 946-954.
12. O’Brien WA, Hartigan PM, Martin D, et al. Changes in plasma HIV-1 RNA and CD4 lymphocyte counts and the risk of progression to AIDS N Engl J Med 1996;334: 426-431.
13. Welles SL, Jackson JB, Yen-Lieberman B, et al. Prognostic value of plasma human immunodeficiency virus type 1 (HIV-1) RNA levels in patients with advanced HIV-1 disease and with little or no zidovudine therapy J Infect Dis 1996;174: 696-703.
14. Pedersen C, Lindhardt BO, Jensen BL, et al. Clinical course of primary HIV infection: consequences for subsequent course of infection Br Med J 1989;299: 154-157.
15. Stalder N, Sudre P, Olmari M, et al. Cytomegalovirus retinitis: decreased risk of bilaterality with increased use of systemic treatment. Swiss HIV Cohort Study Group Clin Infect Dis 1997;24: 620-624.
16. Pepose JS, Nestor MS, Holland GN, et al. An analysis of retinal cotton-wool spots and cytomegalovirus retinitis in the acquired immunodeficiency syndrome Am J Ophthalmol 1983;95: 118-119.
17. Newsome DA, Green W, Miller ED, et al. Microvascular aspects of acquired immune deficiency syndrome retinopathy Am J Ophthalmol 1984;98: 590-601.
18. Freeman WR, Chen A, Henderly DE, et al. Prevalence and significance of acquired immunodeficiency syndrome-related retinal microvasculopathy Am J Ophthalmol 1989;107: 229-235.
19. Cole EL, Meisler DM, Calabrese LH, et al. Herpes zoster ophthalmicus and acquired immune deficiency syndrome Arch Ophthalmol 1984;102: 1027-1029.
20. Sandor EV, Millman A, Croxson TS, et al. Herpes zoster ophthalmicus in patients at risk for the acquired immune deficiency syndrome (AIDS) Am J Ophthalmol 1986;101: 153-155.
21. Jabs DA, Drye L, Van Natta ML, et al. Incidence and long-term outcomes of the human immunodeficiency virus neuroretinal disorder in patients with AIDS Ophthalmology 4, 2015;122: 760-768.
22. Update: Acquired Immunodeficiency Syndrome – United States. MMWR Morb Mortal Wkly Rep 1986;35: 757-766.
23. Glasgow BJ, Engstrom Jr RE, Holland GN, et al. Bilateral endogenous fusarium endophthalmitis associated with acquired immunodeficiency syndrome Arch Ophthalmol 1996;114: 873-877.
24. Holland GN, Engstrom RE, Glasgow BJ, et al. Ocular toxoplasmosis in patients with the acquired immunodeficiency syndrome Am J Ophthalmol 1988;106: 653-667.
25. Toomey CB, Gross A, Lee J, et al. A case of unilateral coccidioidal chorioretinitis in a patient with HIV-associated meningoencephalitis Case Rep Ophthalmol Med 2019;2019: 1475628.
26. Finamor LP, Muccioli C, Martins MC, et al. Ocular and central nervous system paracoccidioidomycosis in a pregnant woman with acquired immunodeficiency syndrome Am J Ophthalmol 2002;134: 456-459.
27. Santos C, Parker J, Dawson C, et al. Bilateral fungal corneal ulcers in a patient with AIDS-related complex Am J Ophthalmol 1985;102: 118-119.
28. Joshi D, O’Grady J, Dietrich D, et al. Increasing burden of liver disease in patients with HIV infection Lancet 9772, 2011;377: 1198-1209.
29. Holland GN, Pepose JS, Pettit TH, et al. Acquired immune deficiency syndrome, ocular manifestations Ophthalmology 1983;90: 859-873.
30. Geier SA, Schielke E, Klauss V, et al. Retinal microvasculopathy and reduced cerebral blood flow in patients with acquired immunodeficiency syndrome Am J Ophthalmol 1992;113: 100-101.
31. Collins FL, et al. Assessment of retinal microvascular health by optical coherence tomography angiography among persons with HIV. AIDS 2021;35(8):1321-1324
32. Kozak I, Bartsch DU, Cheng L, et al. In vivo histology of cotton-wool spots using high resolution optical coherence tomography Am J Ophthalmol 4, 2006;141: 748-750.
33. Gomez ML, Mojana F, Bartsch DU, et al. Imaging of long-term retinal damage after resolved cotton wool spots Ophthalmology 12, 2009;116: 2407-2414.
34. Plummer DJ, Arevalo JF, Fram N, et al. Effectiveness of entoptic perimetry for locating peripheral scotomas caused by cytomegalovirus retinitis Arch Ophthalmol 1996;114: 828-831.
35. Freeman WR, Van Natta ML, Jabs DA, et al. Vision function in HIV-infected individuals without retinitis: report of the Studies of Ocular Complications of AIDS Research Group Am J Ophthalmol 2008;145: 453-462.
36. Jabs DA, Drye L, Van Natta ML, et al. Incidence and long-term outcomes of the human immunodeficiency virus neuroretinal disorder in patients with AIDS Ophthalmology 4, 2015;122: 760-768.
37. McDonald CK & Kuritzkes DR. Human immunodeficiency virus type 1 protease inhibitors Arch Intern Med 1997;157: 951-959.
38. Gulick RM, Mellor JW, Havlir D, et al. Treatment with indinavir, zidovudine, and lamivudine in adults with human immunodeficiency virus infection and prior antiretroviral therapy N Engl J Med 1997;337: 734-739.
39. Hammer SM, Squires KE, Hughes MD, et al. A controlled trial of two nucleoside analogues plus indinavir in persons with human immunodeficiency virus infection and CD4 cell counts of 200 per cubic millimeter or less N Engl J Med 1997;337: 725-733.
40. Ledergerber B, Egger M, Opravil M, et al. Clinical progression and virological failure on highly active antiretroviral therapy in HIV-1 patients: a prospective cohort study. Swiss HIV Cohort StudyLancet 1999;353: 863-881.
41. Cervia JS & Smith MA. Enfuvirtide (T-20): a novel human immunodeficiency virus type 1 fusion inhibitor Clin Infect Dis 2003;37: 1102-1106.
42. Chun T, Stuyver L, Mezell S, et al. Presence of an inducible HIV-1 latent reservoir during highly active antiretroviral therapy Proc Natl Acad Sci USA 1997;94: 13193-13197.
43. Henderly DE, Freeman WR, Smith RE, et al. Cytomegalovirus retinitis as the initial manifestation of the acquired immune deficiency syndrome. Am J Ophthalmol. 1987;103:316–320.
44. Holland GN, Pepose JS, Pettit TH, et al. Acquired immune deficiency syndrome, ocular manifestations. Ophthalmology. 1983;90:859–873.
45. Henderly DE, Freeman WR, Causey DM, et al. Cytomegalovirus retinitis and response to therapy with ganciclovir. Ophthalmology. 1987;94:425–434.
46. Jabs DA, Bartlett JG. AIDS and ophthalmology: a period of transition. Am J Ophthalmol. 1997;124:227–233.
47. Leger F, Vital C, Vital A, et al. Pathologic correlations between ocular and cerebral lesions in 36 AIDS patients. Clin Neuropathol. 1997;16:45–48.
48. Livingston PG, Kerr NC, Sullivan JL. Ocular disease in children with vertically acquired human immunodeficiency virus infection. J AAPOS. 1998;2:177–181.
49. Du LT, Coats DK, Kline MW, et al. Incidence of presumed cytomegalovirus in HIV-infected pediatric patients. J AAPOS. 1999;3:245–249.
50. Baumal CR, Levin AV, Read SE. Cytomegalovirus retinitis in immunosuppressed children. Am J Ophthalmol. 1999;127:550–558.
51. Brody JM, Butrus SI, Laby DM, et al. Anterior segment findings in AIDS patients with cytomegalovirus retinitis. Graefes Arch Clin Exp Ophthalmol. 1995;233:374–376.
52. Saran BR, Pomilla PV. Retinal vascular nonperfusion and retinal neovascularization as a consequence of cytomegalovirus retinitis and cryptococcal choroiditis. Retina. 1996;16:510–512.
53. Cogan DG. Immunosuppression and eye disease. Am J Ophthalmol. 1977;83:777–788.
54. Egbert PR, Pollard RB, Gallagher JG, et al. Cytomegalovirus retinitis in immunosuppressed hosts. II. Ocular manifestations. Ann Intern Med. 1980;93:664.
55. DeVenecia G, Zu Rhein GM, Pratt MV, et al. Cytomegalic inclusion retinitis in an adult, a clinical, histopathologic, and ultrastructural study. Arch Ophthalmol. 1971;86:44.
56. Friedman AH, Orellana J, Freeman WR, et al. Cytomegalovirus retinitis: a manifestation of the acquired immune deficiency syndrome (AIDS). Br J Ophthalmol. 1983;67:372–380.
57. Kennedy PGE, Newsome DA, Hess J, et al. Cytomegalovirus but not human T lymphotropic virus type III/ lymphadenopathy associated virus detected by in-situ hybridization in retinal lesions in patients with the acquired immune deficiency syndrome. Br Med J. 1986;293:162–164.
58. Leger F, Vital C, Vital A, et al. Pathologic correlations between ocular and cerebral lesions in 36 AIDS patients. Clin Neuropathol. 1997;16:45–48.
59. Livingston PG, Kerr NC, Sullivan JL. Ocular disease in children with vertically acquired human immunodeficiency virus infection. J AAPOS. 1998;2:177–181.
60. Du LT, Coats DK, Kline MW, et al. Incidence of presumed cytomegalovirus in HIV-infected pediatric patients. J AAPOS. 1999;3:245–249.
61. Baumal CR, Levin AV, Read SE. Cytomegalovirus retinitis in immunosuppressed children. Am J Ophthalmol. 1999;127:550–558.
62. Freeman WR, Lerner CW, Mines JA, et al. A prospective study of the ophthalmologic findings in the acquired immune deficiency syndrome. Am J Ophthalmol. 1984;97:133–142.
63. Henderly DE, Freeman WR, Smith RE, et al. Cytomegalovirus retinitis as the initial manifestation of the acquired immune deficiency syndrome. Am J Ophthalmol. 1987;103:316–320.
64. Palestine AG, Stevens G, Lane HC, et al. Treatment of cytomegalovirus retinitis with dihydroxy propoxymethyl guanine. Am J Ophthalmol. 1986;101:95–101.
65. Wu AW, Coleson LC, Holbrook J, et al. Measuring visual function and quality of life in patients with cytomegalovirus retinitis: development of a questionnaire. [for; Studies of Ocular Complications of AIDS Research Group] Arch Ophthalmol. 1996;114:841–847.
66. Studies of Ocular Complications of AIDS Research Group in collaboration with the AIDS Clinical Trials Group. Assessment of cytomegalovirus retinitis – clinical evaluation vs centralized grading of fundus photographs. Arch Ophthalmol. 1996;114:791–805.
67. Studies of Ocular Complications of AIDS Research Group in collaboration with the AIDS Clinical Trials Group. Clinical vs photographic assessment of treatment of cytomegalovirus retinitis. Foscarnet–ganciclovir cytomegalovirus retinitis trial report 8. Arch Ophthalmol. 1996;114:848–855.
68. Wongchaisuwat N, Khongpipatchaisiri S, Boonsopon S, Choopong P, Tesavibul N, Prakhunhungsit S, Thoongsuwan S, Rodanant N, Phasukkijwatana N. Extralesional microvascular and structural macular abnormalities in cytomegalovirus retinitis. Sci Rep 2020;10(1):21432.
69. Minkler DS, Mcleon EB, Shaw CM, et al. Herpes virus hominis encephalitis and retinitis. Arch Ophthalmol.1976;94:89–95.
70. Freeman WR, Thomas EL, Rao NA, et al. Demonstration of herpes group virus in the acute retinal necrosis syndrome.Am J Ophthalmol. 1986;102:701–709.
71. Young SJ, Bird AC. Bilateral acute retinal necrosis. Br Ophthalmol. 1978;62:581–590.
72. Holland GN, Engstrom RE, Glasgow BJ, et al. Ocular toxoplasmosis in patients with the acquired immunodeficiency syndrome. Am J Ophthalmol. 1988;106:653–667.
73. Egbert PR, Pollard RB, Gallagher JG, et al. Cytomegalovirus retinitis in immunosuppressed hosts. II. Ocular manifestations. Ann Intern Med. 1980;93:664.
74. Studies of Ocular Complications of AIDS Research Group in collaboration with the AIDS Clinical Trials Group. Clinical vs photographic assessment of treatment of cytomegalovirus retinitis. Foscarnet–ganciclovir cytomegalovirus retinitis trial report 8. Arch Ophthalmol. 1996;114:848–855.
75. Roarty JD, Fisher EJ, Nussbaum JJ. Long-term visual morbidity of cytomegalovirus retinitis in patients with acquired immune deficiency syndrome. Ophthalmology. 1993;100:1685–1688.
76. Studies of Ocular Complications of AIDS Research Group in collaboration with the AIDS Clinical Trials Group. Foscarnet–ganciclovir cytomegalovirus retinitis trial 4 – visual outcomes. Ophthalmology. 1994;101:1250–1261.
77. Collaborative DHPG Treatment Study Group. Treatment of serious cytomegalovirus infections with 9-(1,3-dihydroxy-2- propoxymethyl) guanine in patients with AIDS and other immunodeficiencies. N Engl J Med. 1986;314:801–805.
78. Jabs DA. Cytomegalovirus retinitis and the acquired immunodeficiency syndrome – bench to bedside: LXVII Edward Jackson Memorial lecture. Am J Ophthalmol. 2011;151(2):198–216.
79. Stalder N, Sudre P, Olmari M, et al. Cytomegalovirus retinitis: decreased risk of bilaterality with increased use of systemic treatment. Swiss HIV Cohort Study Group. Clin Infect Dis. 1997;24:620–624.
80. Martin DF, Kuppermann BD, Wolitz RA, et al. Oral ganciclovir for patients with cytomegalovirus retinitis treated with a ganciclovir implant. Roche Ganciclovir Study Group. N Engl J Med. 1999;340:1063–1070.
81. Jabs DA, Martin BK, Forman MS. Cytomegalovirus resistance to ganciclovir and clinical outcomes of patients with cytomegalovirus retinitis. Ophthalmology. 2003;135:26– 34.
82. Holland GN, Sidikaro Y, Kreiger AE, et al. Treatment of cytomegalovirus retinopathy with ganciclovir. Ophthalmology. 1987;94:815–823.
83. Jacobson MA, O’Donnell JJ, Porteous D, et al. Retinal and gastrointestinal disease due to cytomegalovirus in patients with the acquired immune deficiency syndrome: prevalence, natural history, and response to ganciclovir therapy. Q J Med. 1988;67:473–486.
84. Jabs DA, Enger C, Bartlett JG. Cytomegalovirus retinitis and acquired immunodeficiency syndrome. Arch Ophthalmol. 1989;107:75–80.
85. Martin DF, Sierra-Madero J, Walmsley S, et al. A controlled trial of valganciclovir as induction therapy for cytomegalovirus retinitis. N Engl J Med. 2002;346:1119–1126.
86. Lalezari J, Lindley J, Walmsley S, et al. A safety study of oral valganciclovir maintenance treatment of cytomegalovirus retinitis. J Acquir Immune Defic Syndr. 2002;30:392–400.
87. Bergdahl S, Sonnerbor A, Larsson A, et al. Declining levels of HIV p24 antigen in serum during treatment with foscarnet. Lancet. 1988;1:1052.
88. Crumpacker CS, Kowalsky PN, Oliver SA, et al. Resistance of herpes simplex virus to 9-[[2-(hydroxymethyl) ethoxy]methyl] guanine (2-NDG); physical mapping of drug synergism within the viral DNA polymerase locus. Proc Natl Acad Sci USA. 1984;81:1556–1560.
89. Lalezari JP, Stagg RJ, Kuppermann BD, et al. Intravenous cidofovir for peripheral cytomegalovirus retinitis in patients with AIDS: a randomized, controlled trial. Ann Intern Med. 1997;126:257–263.
90. Studies of Ocular Complications of AIDS Research Group in collaboration with the AIDS Clinical Trials Group. Long- term follow-up of patients with AIDS treated with parenteral cidofovir for cytomegalovirus: the HPMPC Peripheral Cytomegalovirus Retinitis Trial. AIDS. 2000;14:1571–1581.
91. Studies of Ocular Complications of AIDS Research Group in collaboration with the AIDS Clinical Trials Group. Parenteral cidofovir for cytomegalovirus retinitis in patients with AIDS: the HPMPC peripheral cytomegalovirus retinitis trial – a randomized, controlled trial. Ann Intern Med. 1997;126:264–274.
92. Rahhal FM, Arevalo JF, Chavez de la Paz E, et al. Treatment of cytomegalovirus retinitis with intravitreous cidofovir in patients with AIDS: a preliminary report. Ann Intern Med. 1996;125:98–103.
93. Schachat, Andrew P. Ryan’s Retina. Seventh edition. Edinburgh; New York: Elsevier, 2022.
94. Patton ME, Su JR, Nelson R, et al. Primary and secondary syphilis – United States, 2005–2013. MMWR Morb Mortal Wkly Rep. 2014;63(18):402–406.
95. World Health Organization. Global incidence and prevalence of selected curable sexually transmitted infections 2008. World Health Organization: Geneva; 2012.
96. Davis JL. Ocular syphilis. Curr Opin Ophthalmol. 2014;25(6):513–518.
97. Schachat, Andrew P. Ryan’s Retina. Seventh edition. Edinburgh ; New York: Elsevier, 2022.
98. Marra M. Update on neurosyphilis. Curr Infect Dis Rep. 2009;11(2):127–134.
99. Jones NP. The Manchester Uveitis Clinic: the first 3000 patients – epidemiology and casemix. Ocul Immunol Inflamm. 2015;23(2):118–126.
100. Kuo IC, Kapusta MA, Rao NA. Vitritis as the primary manifestation of ocular syphilis in patients with HIV infection. Am J Ophthalmol. 1998;125(3):306–311.
101. Passo MS, Rosenbaum JT. Ocular syphilis in patients with human immunodeficiency virus infection. Am J Ophthalmol. 1988;106(1):1–6.
102. Gass JD, Braunstein RA, Chenoweth RG. Acute syphilitic posterior placoid chorioretinitis. Ophthalmology. 1990;97(10):1288–1297.
103. Song JH, Hong YT, Kwon OW. Acute syphilitic posterior placoid chorioretinitis following intravitreal triamcinolone acetonide injection. Graefes Arch Clin Exp Ophthalmol. 2008;246(12):1775–1778.
104. Browning DJ. Posterior segment manifestations of active ocular syphilis, their response to a neurosyphilis regimen of penicillin therapy, and the influence of human immunodeficiency virus status on response. Ophthalmology. 2000;107(11):2015–2023.
105. Villanueva AV, Sahouri MJ, Ormerod LD, et al. Posterior uveitis in patients with positive serology for syphilis. Clin Infect Dis. 2000;30(3):479–485.
106. Miura G, et al. Ocular syphilis with optic disc neovascularization treated with bevacizumab evaluated by OCT angiography and electroretinography. J Ophthalmic Inflamm Infect. 2020 Oct 30;10(1):28.
107. Dowell D, Polgreen PM, Beekmann SE, et al. Dilemmas in the management of syphilis: a survey of infectious diseases experts. Clin Infect Dis. 2009;49(10):1526–1529.
108. Song JH, Hong YT, Kwon OW. Acute syphilitic posterior placoid chorioretinitis following intravitreal triamcinolone acetonide injection. Graefes Arch Clin Exp Ophthalmol. 2008;246(12):1775–1778.
109. Chorba TL, Berkelman RL, Safford SK, et al. Mandatory reporting of infectious diseases by clinicians. JAMA. 1989;262(21):3018–3026.
110. World Health Organization. Global Tuberculosis Report 2019. Geneva: World Health Organization; 2019. Available at: https://www.who.int/teams/global-tuberculosis-programme/tb-reports/global-tuberculosis-report-2021.
111. Wroblewski KJ, Hidayat AA, Neafie RC, et al. Ocular tuberculosis: a clinicopathologic and molecular study Ophthalmology 2011;118: 772-777.
112. Griffith DE, Aksamit T, Brown-Elliott BA, et al. An official ATS/IDSA statement: diagnosis, treatment, and prevention of nontuberculous mycobacterial diseases Am J Respir Crit Care Med 2007;15: 367-416
113. Rathinam SR & Lalitha P. Paradoxical worsening of ocular tuberculosis in HIV patients after antiretroviral therapy Eye (Lond) 2007;21: 667-668.
114. Schachat, Andrew P. Ryan’s Retina. Seventh edition. Edinburgh; New York: Elsevier, 2022.
115. Gupta A, Bansal R, Gupta V, et al. Ocular signs predictive of tubercular uveitis Am J Ophthalmol 2010;149: 562570.
116. Vasconcelos-Santos DV, Rao PK, Davies JB, et al. Clinical features of tuberculous serpiginouslike choroiditis in contrast to classic serpiginous choroiditis Arch Ophthalmol 2010;128: 853-858.
117. Rathinam SR & Namperumalsamy P. Global variation and pattern changes in epidemiology of uveitis Indian J Ophthalmol 2007;55: 173-183.
118. Krassas N, Wells J, Bell C, et al. Presumed tuberculosis-associated uveitis: rising incidence and widening criteria for diagnosis in a non-endemic area Eye (Lond) 2018;32: 87-92.
119. Rao NA, Saraswathy S & Smith RE. Tuberculous uveitis: distribution of Mycobacterium tuberculosis in the retinal pigment epithelium Arch Ophthalmol 2006;124: 1777-1779.
120. Agarwal A, Agrawal R, Khandelwal N, et al. Choroidal structural changes in tubercular multifocal serpiginoid choroiditis Ocul Immunol Inflamm 2018;26: 838-844.
121. Dorhoi A, Reece ST & Kaufmann SHE. For better or for worse: the immune response against Mycobacterium tuberculosis balances pathology and protection Immunol Rev 2011;240: 235-251.
122. Krishnan N, Robertson BD & Thwaites G. The mechanisms and consequences of the extra-pulmonary dissemination of Mycobacterium tuberculosis Tuberculosis (Edinb) 2010;90: 361-366
123. Tummala GC, Chu Z, Weinstein JE, Wang RK, Pepple KL. Swept source OCTA reveals a link between choriocapillaris blood flow and vision loss in a case of tubercular serpiginous-like choroiditis. Am J Ophthalmol Case Rep 2021;21:101018.
124. Albini TA, Karakousis PC & Rao NA. Interferon-gamma release assays in the diagnosis of tuberculous uveitis Am J Ophthalmol 2008;146: 486-488.
125. Rathinam SR. Tubercular uveitis and scleritis Focal Points (AAO) 2017;35: 1-15.
126. Oliveira SBV de, Passos F, Hadad DJ, et al. The impact of ocular tuberculosis on vision after two months of intensive therapy Braz J Infect Dis 2018;22: 159-165.
127. Anibarro L, Cortés E, Chouza A, et al. Early treatment of tuberculous uveitis improves visual outcome: a 10-year cohort study Infection 2018;46: 549-554.
128. Kadhiravan T & Deepanjali S. Role of corticosteroids in the treatment of tuberculosis: an evidence-based update Indian J Chest Dis Allied Sci 2010;52: 153-158.
129. Rathinam SR. Treating uveitis in the developing world setting Int Ophthalmol Clin 2010;50: 219-228.
130. Urayama A, Yamada N, Sasaki T, et al. Unilateral acute uveitis with retinal periarteritis and detachment Jpn J Clin Ophthalmol 1971;25: 607-619.
131. Anthony CL, Bavinger JC, Yeh S. Advances in the diagnosis and management of acute retinal necrosis. Ann Eye Sci 2020;5:28.
132. Holland GN, Cornell PJ, Park MS, et al. An association between acute retinal necrosis syndrome and HLA-DQw7 and phenotype Bw62, DR4 Am J Ophthalmol 4, 1989;108: 370-374.
133. Ichikaw T, Sakai J & Usui M. HLA antigens of patients with Kirisawa’s uveitis and herpetic keratitisAtarashii Ganka 1989;6: 107-114.
134. Lau CH, Missotten T, Salzmann J, et al. Acute retinal necrosis features, management, and outcomesOphthalmology 4, 2007;114: 756-762.
135. Lim HK, Seppanen M, Hautala T, et al. TLR3 deficiency in herpes simplex encephalitis: high allelic heterogeneity and recurrence risk Neurology 2014;83: 1888-1897.
136. Ganatra JB, Chandler D, Santos C, et al. Viral causes of the acute retinal necrosis syndrome Am J Ophthalmol 2, 2000;129: 166-172.
137. Silverstein BE, Conrad D, Margolis TP, et al. Cytomegalovirus-associated acute retinal necrosis syndrome Am J Ophthalmol 2, 1997;123: 257-258.
138. Kramer S, Brummer C & Zierhut M. Epstein–Barr virus associated acute retinal necrosis Br J Ophthalmol 1, 2001;85: 114.
139. Papageorgiou E, Ch’ng S, Kulkarni A, et al. Fourth cranial nerve palsy and bilateral acute retinal necrosis following human herpesvirus 6 infection of the central nervous system Ocul Immunol Inflamm 3, 2014;22: 228-232.
140. Ozdemir HB & Ozdal PC. Human adenovirus: an unusual causative agent for acute retinal necrosis presented with central retinal vascular occlusion Ocul Immunol Inflamm 5, 2020;28: 749-753.
141. Pawlitzki M, Teuber J, Campe C, et al. VZV-associated acute retinal necrosis in a patient with MS treated with natalizumab Neurol Neuroimmunol Neuroinflamm 2018;5: e475.
142. Kucukevcilioglu M, Eren M, Yolcu U, et al. Acute retinal necrosis following intravitreal dexamethasone (Ozurdex®) implant Arq Bras Oftalmol 2, 2015;78: 118-119.
143. Ramaiya KJ & Rao PK. Herpetic necrotizing retinitis following flucinolone acetonide intravitreal implant Ocul Immunol Inflamm 1, 2011;19: 72-74.
144. Heath G, Depledge DP, Brown JR, et al. Acute retinal necrosis caused by the zoster vaccine virusClin Infect Dis 2017;65: 2122-2125.
145. Vann VR & Atherton SS. Neural spread of herpes simplex virus after anterior chamber inoculationInvest Ophthalmol Vis Sci 9, 1991;32: 2462-2472.
146. Muthiah MN, Michaelides M, Child CS, et al. Acute retinal necrosis: a national population-based study to assess the incidence, methods of diagnosis, treatment strategies and outcomes in the UK Br J Ophthalmol 11, 2007;91: 1452-1455.
147. Sado K, Kimura T, Hotta Y, et al. Acute retinal necrosis syndrome associated with herpes simplex keratitis Retina 3, 1994;14: 260-263.
148. Hiroshi T, Hiroshi G, Kenichi N, et al. Clinical Characteristics, Management, and Factors Associated with Poor Visual Prognosis of Acute Retinal Necrosis, Ocular Immunology and Inflammation, (2022) 30:1, 48-53
149. Duker JS, Nielsen JC, Eagle Jr RC, et al. Rapidly progressive acute retinal necrosis secondary to herpes simplex virus, type 1 Ophthalmology 12, 1990;97: 1638-1643.
150. Margolis T, Irvine AR, Hoyt WF, et al. Acute retinal necrosis syndrome presenting with papillitis and arcuate neuroretinitis Ophthalmology 7, 1988;95: 937-940.
151. Fox GM & Blumenkranz M. Giant retinal pigment epithelial tears in acute retinal necrosis Am J Ophthalmol 3, 1993;116: 302-306.
152. Matsuo T, Date S, Tsuji T, et al. Immune complex containing herpesvirus antigen in a patient with acute retinal necrosis Am J Ophthalmol 3, 1986;101: 368-371.
153. Ahmadieh H, Soheilian M, Azarmina M, et al. Surgical management of retinal detachment secondary to acute retinal necrosis: clinical features, surgical techniques, and long-term results Jpn J Ophthalmol 5, 2003;47: 484-491.
154. Lei B, Jiang R, Wang Z, et al. Bilateral acute retinal necrosis: a case series Retina 2020;40: 145-153.
155. Browning DJ, Blumenkranz MS, Culbertson WW, et al. Association of varicella zoster dermatitis with acute retinal necrosis syndrome Ophthalmology 6, 1987;94: 602-606.
156. Forster DJ, Dugel PU, Frangieh GT, et al. Rapidly progressive outer retinal necrosis in the acquired immunodeficiency syndrome Am J Ophthalmol 4, 1990;110: 341-348.
157. Holland GN. Standard diagnostic criteria for the acute retinal necrosis syndrome. Executive Committee of the American Uveitis Society Am J Ophthalmol 5, 1994;117: 663-667.
158. Standardization of Uveitis Nomenclature (SUN) Working Group, Classification Criteria for Acute Retinal Necrosis Syndrome, Am J Ophthalmol,2021 Aug;228:237-244
159. Harper TW, Miller D, Schiffman JC, et al. Polymerase chain reaction analysis of aqueous and vitreous specimens in the diagnosis of posterior segment infectious uveitis Am J Ophthalmol 2009;147: 140-147.e2.
160. Jain A, Anantharaman G, Gopalakrishnan M,Narayanan S. Sequential optical coherence tomography images of early acute retinal necrosis. Indian J Ophthalmol 2020;68:520-2.
Ohtake-Matsumoto, A., Keino, H., Koto, T. et al. Spectral domain and swept source optical coherence tomography findings in acute retinal necrosis. Graefes Arch Clin Exp Ophthalmol 253, 2049–2051 (2015).
161. Hisayo T, Kyoko OM, Masato H et al. Indocyanine green angiographic findings in acute retinal necrosis, Jpn J Ophthalmol. May-Jun 2002;46(3):330-5.
162. Costa de Andrade G, Marchesi Mello LG, Martines GC, optical coherence tomography angiography findings in acute retinal necrosis, Retinal cases & brief reports 0:1–5, 2018.
163. Balansard B, Bodaghi B, Cassoux N, et al. Necrotising retinopathies simulating acute retinal necrosis syndrome Br J Ophthalmol 2005;89: 96-101.
164. Emerson GG, Smith JR, Wilson DJ, et al. Primary treatment of acute retinal necrosis with oral antiviral therapy Ophthalmology 12, 2006;113: 2259-2261.
165. Figueroa MS, Garabito I, Gutierrez C, et al. Famciclovir for the treatment of acute retinal necrosis (ARN) syndrome Am J Ophthalmol 2, 1997;123: 255-257.
166. Aslanides IM, De Souza S, Wong DT, et al. Oral valacyclovir in the treatment of acute retinal necrosis syndrome Retina 3, 2002;22: 352-354.
167. Savant V, Saeed T, Denniston A, et al. Oral valganciclovir treatment of varicella zoster virus acute retinal necrosis Eye (Lond) 5, 2004;18: 544-545.
168. La Cava M, Abbouda A, Restivo L, et al. Delayed onset of bilateral acute retinal necrosis syndrome: a 46-year interval Semin Ophthalmol 2, 2015;30: 146-149.
169. Schoenberger SD, Kim SJ, Thorne JE, et al. Diagnosis and treatment of acute retinal necrosis: a report by the American Academy of Ophthalmology Ophthalmology 2017;124: 382-392.
170. Han DP, Lewis H, Williams GA, et al. Laser photocoagulation in the acute retinal necrosis syndrome Arch Ophthalmol 8, 1987;105: 1051-1054.
171. Ishida T, Sugamoto Y, Sugita S, et al. Prophylactic vitrectomy for acute retinal necrosis Jpn J Ophthalmol 5, 2009;53: 486-489.
172. Han DP, Lewis H, Williams GA, et al. Laser photocoagulation in the acute retinal necrosis syndrome Arch Ophthalmol 8, 1987;105: 1051-1054.
173. Ishida T, Sugamoto Y, Sugita S, et al. Prophylactic vitrectomy for acute retinal necrosis Jpn J Ophthalmol 5, 2009;53: 486-489.
174. Ando F, Kato M, Goto S, et al. Platelet function in bilateral acute retinal necrosis Am J Ophthalmol 1, 1983;96: 27-32.
176. Smith JR, Ashander LM, Arruda SL, Pathogenesis of ocular toxoplasmosis Progress in Retinal and Eye Research Volum 81, March 2021, 100882
177. Nussenblatt RB. Ocular toxoplasmosis Nussenblatt RB, Whitcup SM & Palestine AG. Uveitis: fundamentals and clinical practice 2nd ed 1996; Mosby–Year Book, Inc St. Louis 211-228.
178. Oliver, G.F., Ferreira, L.B., Vieira, B.R. et al. Posterior segment findings by spectral-domain optical coherence tomography and clinical associations in active toxoplasmic retinochoroiditis. Sci Rep 12, 1156 (2022).
179. Jones JL, Kruszon-Moran D, Wilson M, et al. Toxoplasma gondii infection in the United States: seroprevalence and risk factors Am J Epidemiol 2001;154: 357-365
180. Gonzalez Fernandez D, Nascimento H, et al. Uveitis in Sao Paulo, Brazil: 1053 new patients in 15 months Ocul Immunol Inflamm 3, 2017;25: 382-387.
181. Holland GN. Ocular toxoplasmosis: a global reassessment. Part I: epidemiology and course of diseaseAm J Ophthalmol 6, 2003;136: 973-988.
182. H, Asseraf M, Yera H, et al. Contributions of immunoblotting, real-time PCR, and the Goldmann–Witmer coefficient to diagnosis of atypical toxoplasmic retinochoroiditis J Clin Microbiol 7, 2009;47: 2131-2135.
183. Montoya JG & Liesenfeld O. Toxoplasmosis Lancet 9425, 2004;363: 1965-1976.
184. Bowie WR & King AS. Outbreak of toxoplasmosis associated with municipal drinking water Lancet 1997;350: 173-178.
185. Tenter AM, Heckeroth AR & Weiss LM. Toxoplasma gondii: from animals to humans Int J Parasitol 12–13, 2000;30: 1217-1258.
186. Holland GN. Ocular toxoplasmosis: a global reassessment. Part II: Disease manifestations and management Am J Ophthalmol 2004;137: 1-17.
187. Arevalo JF, Belfort Jr R, Muccioli C, et al. Ocular toxoplasmosis in the developing world Int Ophthalmol Clin 2, 2010;50: 57-69
188. Hovakimyan A & Cunningham Jr ET. Ocular toxoplasmosis Ophthalmol Clin North Am 3, 2002;15: 327-332.
189. Pleyer U, Torun N & Liesenfeld O. Ocular toxoplasmosis Ophthalmologe 7, 2007;104: 603-15; quiz 616.
190. Tabbara KF. Ocular toxoplasmosis Int Ophthalmol 5–6, 1990;14: 349-351.
191. Holland GN, Engstrom Jr RE, Glasgow BJ, et al. Ocular toxoplasmosis in patients with the acquired immunodeficiency syndrome Am J Ophthalmol 6, 1988;106: 653-667.
192. Smith JR & Cunningham Jr ET. Atypical presentations of ocular toxoplasmosis Curr Opin Ophthalmol 6, 2002;13: 387-392.
193. Rothova A. Ocular manifestations of toxoplasmosis Curr Opin Ophthalmol 6, 2003;14: 384-388.
194. London NJ, Hovakimyan A, Cubillan LD, et al. Prevalence, clinical characteristics, and causes of vision loss in patients with ocular toxoplasmosis Eur J Ophthalmol 6, 2011;21: 811-819.
195. Vallochi AL, Nakamura MV, Schlesinger D, et al. Ocular toxoplasmosis: more than just what meets the eye Scand J Immunol 2002;55: 324-328.
196. Azar G, Favard C, Salah S, et al. Optical Coherence Tomography Angiography Analysis of Retinal and Choroidal Vascular Networks during Acute, Relapsing, and Quiescent Stages of Macular Toxoplasma Retinochoroiditis BioMed Research International Volume 2020
197. Atmaca, L.S., Simsek, T., Atmaca Sonmez, P. et al. Fluorescein and indocyanine green angiography in ocular toxoplasmosis. Graefe’s Arch Clin Exp Ophthalmol 244, 1688–1691 (2006).
198. Mathis T, Delaunay B, Favard C et al. Hyperautofluorescent spots in acute ocular toxoplasmosis, Retina 40:2396–2402, 2020
199. Matos K, Muccioli C, Belfort Junior R, et al. Correlation between clinical diagnosis and PCR analysis of serum, aqueous, and vitreous samples in patients with inflammatory eye disease Arq Bras Oftalmol 2007;70: 109-114.
200. Gomez CA, Sahoo MK, Kahn GY, et al. Dual-target, real-time PCR for the diagnosis of intraocular Toxoplasma gondii infections Br J Ophthalmol 4, 2019;103: 569-572.
201. Pradhan E, Bhandari S, Gilbert RE, et al. Antibiotics versus no treatment for toxoplasma retinochoroiditis Cochrane Database Syst Rev 5, 2016; CD002218.
202. Stanford MR & Gilbert RE. Treating ocular toxoplasmosis: current evidence Mem Inst Oswaldo Cruz 2, 2009;104: 312-315.
203. Fernandes Felix JP, Cavalcanti Lira RP, Grupenmacher AT, et al. Long-term results of trimethoprim-sulfamethoxazole versus placebo to reduce the risk of recurrent Toxoplasma gondiiretinochoroiditis Am J Ophthalmol 2020;213: 195-202.
204. Silveira C, Muccioli C, Nussenblatt R, et al. The effect of long-term intermittent trimethoprim/sulfamethoxazole treatment on recurrences of toxoplasmic retinochoroiditis: 10 years of follow-up Ocul Immunol Inflamm 3, 2015;23: 246-247.
205. Zamora YF, Arantes T, Reis FA, et al. Local treatment of toxoplasmic retinochoroiditis with intravitreal clindamycin and dexamethasone Arq Bras Oftalmol 4, 2015;78: 216-219.
206. Van Gelder RN & Leveque TK. Cataract surgery in the setting of uveitis Curr Opin Ophthalmol 1, 2009;20: 42-45.
207. Smith SR, Kroll AJ, Lou PL, et al. Endogenous bacterial and fungal endophthalmitis Int Ophthalmol Clin 2, 2007;47: 173-183.
208. Cunningham ET, Flynn HW, Relhan N, et al. Endogenous endophthalmitis Ocul Immunol Inflamm 2018;26: 491-495.
209. Chakrabarti A, Shivaprakash MR, Singh R, et al. Fungal endophthalmitis: fourteen years’ experience from a center in India Retina 10, 2008;28: 1400-1407.
210. Ness T, Pelz K & Hansen LL. Endogenous endophthalmitis: microorganisms, disposition and prognosis Acta Ophthalmol Scand 8, 2007;85: 852-856.
211 Lingappan A, Wykoff CC, Albini TA, et al. Endogenous fungal endophthalmitis: causative organisms, management strategies, and visual acuity outcomes Am J Ophthalmol 1, 2012;153: 162-166.e1.
212. Underhill DM & Iliev ID. The mycobiota: interactions between commensal fungi and the host immune system Nat Rev Immunol 6, 2014;14: 405-416.
213. Pappas PG, Rex JH, Lee J, et al. A prospective observational study of candidemia: epidemiology, therapy, and influences on mortality in hospitalized adult and pediatric patients Clin Infect Dis 5, 2003;37: 634-643.
214. Menezes AV, Sigesmund DA, Demajo WA, et al. Mortality of hospitalized patients with Candidaendophthalmitis Arch Intern Med 18, 1994;154: 2093-2097.
215. Connell PP, O’Neill EC, Amirul Islam FM, et al. Endogenous endophthalmitis associated with intravenous drug abuse: seven-year experience at a tertiary referral center Retina 10, 2010;30: 1721-1725.
216. Datta N, Arendrup MC & Saunte JP. First report of Candida palmioleophila endogenous endophthalmitis Acta Ophthalmol 6, 2015;93: e517-e518.
217. Schiedler V, Scott IU, Flynn HW, et al. Culture-proven endogenous endophthalmitis: clinical features and visual acuity outcomes Am J Ophthalmol 4, 2004;137: 725-731.
218. Nagao M, Saito T, Doi S, et al. Clinical characteristics and risk factors of ocular candidiasis Diagn Microbiol Infect Dis 2, 2012;73: 149-152.
219. Zhuang H, et al. Optical coherence tomography features of retinal lesions in Chinese patients with endogenous Candida endophthalmitis. BMC Ophthalmol 2020;20:52.
220. Riddell J IV, Comer GM & Kauffman CA. Treatment of endogenous fungal endophthalmitis: focus on new antifungal agents Clin Infect Dis 5, 2011;52: 648-653.
221. Roney P, Barr CC, Chun CO, et al. Endogenous Aspergillus endophthalmitis Rev Infect Dis 6, 1986;8: 955-958.
222. Lewis H, Aaberg TM, Fary DR, et al. Latent disseminated blastomycosis with choroidal involvement Arch Ophthalmol 4, 1988;106: 527-530.
223. Lemke A, Kiderlen A & Kayser O. Amphotericin B Appl Microbiol Biotechnol 2, 2005;68: 151-162.
224. Blumenkranz MS & Stevens DA. Endogenous coccidioidal endophthalmitis Ophthalmology 10, 1980;87: 974-984.
225. Green WR, Bennett JE & Goos RD. Ocular penetration of amphotericin B: a report of laboratory studies and a case report of postsurgical Cephalosporium endophthalmitis Arch Ophthalmol 6, 1965;73: 769-775.
226. Dave VP, Majji AB, Suma N, et al. A rare case of Aspergillus terreus endogenous endophthalmitis in a patient of acute lymphoid leukemia with good clinical outcome Eye (Lond) 8, 2011;25: 1094-1096.
227. Pappas PG, Rex JH, Sobel JD, et al. Guidelines for treatment of candidiasis Clin Infect Dis 2, 2004;38: 161-189.
228. Scott LJ & Simpson D. Voriconazole: a review of its use in the management of invasive fungal infections Drugs 2, 2007;67: 269-298
229. Melles RB & Marmor MF. The risk of toxic retinopathy in patients on long-term hydroxychloroquine therapy JAMA Ophthalmol 12, 2014;132: 1453-1460.
230. Mavrikakis I, Sfikakis PP, Mavrikakis E, et al. The incidence of irreversible retinal toxicity in patients treated with hydroxychloroquine: a reappraisal Ophthalmology 7, 2003;110: 1321-1326.
231. Lyons JS & Severns ML. Detection of early hydroxychloroquine retinal toxicity enhanced by ring ratio analysis of multifocal electroretinography Am J Ophthalmol 5, 2007;143: 801-809.
232. Wolfe F & Marmor MF. Rates and predictors of hydroxychloroquine retinal toxicity in patients with rheumatoid arthritis and systemic lupus erythematosus Arthritis Care Res 6, 2010;62: 775-784.
233. Adamptey B, Rudnisky CJ & MacDonald IM. Effect of stopping hydroxychloroquine therapy on the multifocal electroretinogram in patients with rheumatic disorders Can J Ophthalmol 2020;55: 38-44.
234. Marks JS. Chloroquine retinopathy: is there a safe daily dose? Ann Rheum Dis 1, 1982;41: 52-58.
235. Nylander U. Ocular damage in chloroquine therapy Acta Ophthalmol 1967;92: 5-71.
236. Katsman D, Sanfilippo C & Sarraf D. Panretinal degeneration associated with long-term hydroxychloroquine use and heterozygous USH2A mutation Retin Cases Brief Rep Suppl. 1, 2017;11: S77-S80.
237. Corradetti G, Violanti S, Au A, et al. Wide field retinal imaging and the detection of drug associated retinal toxicity Int J Retina Vitreous Suppl. 1, 2019;5: 26.
238. Kellner U, Renner AB & Tillack H. Fundus autofluorescence and mfERG for early detection of retinal alterations in patients using chloroquine/hydroxychloroquine Invest Ophthalmol Vis Sci 8, 2006;47: 3531-3538.
239. Kellner U, Kellner S & Weinitz S. Chloroquine retinopathy: lipofuscin- and melanin-related fundus autofluorescence, optical coherence tomography and multifocal electroretinography Doc Ophthalmol 2, 2008;116: 119-127.
240. Pasadhika S, Fishman GA, Choi D, et al. Selective thinning of the perifoveal inner retina as an early sign of hydroxychloroquine retinal toxicity Eye (Lond) 5, 2010;24: 756-62; quiz 763.
241. Ozek D, Onen M, Karaca EE, et al. The optical coherence tomography angiography findings of rheumatoid arthritis patients taking hydroxychloroquine Eur J Ophthalmol 5, 2019;29: 532-537.
242. Forte R, Haulani H, Dyrda A, et al. Swept source optical coherence tomography angiography in patients treated with hydroxychloroquine: correlation with morphological and functional tests Br J Ophthalmol 9, 2021;105: 1297-1301.
243. HN Tarakcioglu, et al. Is optical coherence tomography angiography a useful tool in the screening of hydroxychloroquine retinopathy? Int Ophthalmol. 2021 Jan;41:27-33
244. Kellner U, Kraus H & Foerster MH. Multifocal ERG in chloroquine retinopathy: regional variance of retinal dysfunction Graefes Arch Clin Exp Ophthalmol 1, 2000;238: 94-97.
245. Tzekov R. Ocular toxicity due to chloroquine and hydroxychloroquine: electrophysiological and visual function correlates Doc Ophthalmol 1, 2005;110: 111-120.
246. Stepien KE, Han DP, Schell J, et al. Spectral-domain optical coherence tomography and adaptive optics may detect hydroxychloroquine retinal toxicity before symptomatic vision loss Trans Am Ophthalmol Soc 2009;107: 28-33.
247. Kim HA, Lee S, Eah KS, et al. Prevalence and risk factors of tamoxifen retinopathyOphthalmology 4, 2020;127: 555-557.
248. Tang R, Shields J, Schiffman J, et al. Retinal changes associated with tamoxifen treatment for breast cancer Eye (Lond) Pt 3, 1997;11: 295-297.
249. Alwitry A & Gardner I. Tamoxifen maculopathy Arch Ophthalmol 10, 2002;120: 1402.
250. Colley SM & Elston JS. Tamoxifen optic neuropathy Clin Exp Ophthalmol 1, 2004;32: 105-106.
251. Nair SN, Anantharaman G, Gopalakrishnan M, et al. Spectral domain optical coherence tomography findings in tamoxifen retinopathy-a case report Retin Cases Brief Rep 2, 2013;7: 128-130.
252. McKeown CA, Swartz M, Blom J, et al. Tamoxifen retinopathy Br J Ophthalmol 3, 1981;65: 177-179.
253. Wang L, Miao H & Li X. Tamoxifen retinopathy: a case report Springerplus 2015;4: 501.
254. Gualino V, Cohen SY, Delyfer MN, et al. Optical coherence tomography findings in tamoxifen retinopathy Am J Ophthalmol Case Rep 4, 2005;140: 757-758.
255. Park SS, Zawadzki RJ, Truong SN, et al. Microcystoid maculopathy associated with tamoxifen use diagnosed by high-resolution fourier-domain optical coherence tomography Retin Cases Brief Rep 1, 2009;3: 33-35.
256. Bourla DH, Sarraf D & Schwartz SD. Peripheral retinopathy and maculopathy in high-dose tamoxifen therapy Am J Ophthalmol Case Rep 1, 2007;144: 126-128.
257. Doshi RR, Fortun JA, Kim BT, et al. Pseudocystic foveal cavitation in tamoxifen retinopathy Am J Ophthalmol 6, 2014;157: 12911298.e3.
258. Lee S, Kim HA & Yoon YH. OCT angiography findings of tamoxifen retinopathy: similarity with macular telangiectasia type 2 Ophthalmol Retina 8, 2019;3: 681-689.
Leopoldo Rubinato, Francesco Di Bin, Valentina Sarao, Daniele Veritti, Paolo Lanzetta
White dots syndromes (WDS) are a group of diseases characterized by idiopathic inflammation and dysfunction of the outer retina, retinal pigment epithelium (RPE), and choroid. This chapter will discuss the features of acute posterior multifocal placoid pigment epitheliopathy (APMPPE), serpiginous choroiditis (SC), multifocal choroiditis (MFC)/punctate inner choroidopathy (PIC), multiple evanescent white dot syndrome (MEWDS), birdshot chorioretinopathy (BCR), acute zonal occult outer retinopathy (AZOOR), acute macular neuroretinopathy (AMN), and acute idiopathic maculopathy (AIM). A viral or an autoimmune etiology have been supposed to contribute to the development of these diseases, but no antiretinal antibodies have been found yet. The age of onset is generally from the second to the sixth decade of life with a strong preponderance in female gender. These conditions may present in one or both eyes with blurred vision, visual field alterations, and photopsias. At the slit-lamp examination, white spots may be subtle or a prominent finding. These diseases are rarely overlapping, and a differential diagnosis can be made with a multimodal approach, using fluorescein angiography (FA), indocyanine green (ICG) angiography, optical coherence tomography (OCT), fundus autofluorescence (FAF), and other techniques. Granulomatous diseases, such as sarcoidosis or tuberculosis, syphilis and intraocular lymphoma, toxoplasmosis and pneumocystis choroidopathy, and Behçet disease have to be considered in the differential diagnosis. The visual prognosis of these conditions is variable from a near complete recovery, such as in MEWDS or in PIC, to an evolutive visual acuity decreasing such as in SC. Therapy could be based on topic, intraocular systemic corticosteroids, or systemic immunosuppressive drugs, but some WDS have no proven treatment. Intravitreal anti-vascular endothelial growth factor (VEGF) agents are recommended in those cases developing choroidal neovascularization (CNV).
Acute posterior multifocal placoid pigment epitheliopathy (APMPPE or AMPPE) was first described in 1968 by Gass. It is usually characterized by multiple, bilateral, cream-colored, placoid lesions at the level of the outer retina/retinal pigment epithelium (RPE) due to idiopathic ischemic alterations of the choriocapillaris that result in injury to the overlying RPE. It usually presents in young patients, equally men or women, that are in the second to fourth decades of life [1]. At the onset, patients complain of central vision loss or blurred vision, paracentral scotoma, metamorphopsia, and photopsias [2]. Generally, the visual symptoms and the fundus appearance improve within 2–4 weeks, and the long-term prognosis tends to be good, but severe vision loss can result from RPE and/or photoreceptor injury, and rarely choroidal neovascularization (CNV) can develop. Recurrences are uncommon [3]. Acutely, fluorescein angiography (FA) reveals early blockage and progressive late leakage, while indocyanine green (ICG) angiography shows early and late hypofluorescence corresponding to those lesions identified
clinically and on FA [1,4]. Optical coherence tomography (OCT) images taken through the lesions show disruption of the outer retinal hyperreflective bands [5]. Typically, treatment for APMPPE is not indicated, although systemic steroids may be considered in cases involving the central region of the macula or in patients with cerebral vasculitis [6]
Serpiginous choroidopathy
Serpiginous choroidopathy (SC), previously known as geographic choroiditis or helicoid peripapillary choroidopathy, is a rare, recurrent, bilateral inflammatory disorder of unknown etiology affecting the outer retina and the choriocapillaris [7]. SC typically occurs in healthy individuals between the ages of 30 and 70 [8]. Patients are often asymptomatic in the early phases of the disease, or they may notice small paracentral scotomas related to the placoid lesions. However, if lesions advance to the fovea, patients may develop significant central vision loss [9]. The acute phase of the disease is classically characterized by deep grey-white or yellow geographic placoid lesions that project from the optic nerve and spread centrifugally. Patients typically lack marked intraocular inflammation, although one third of cases may have vitreous cells [10]. Over the course of weeks, the acute placoid lesions resolve and become atrophic chorioretinal scars. Recurrent episodes are common, and new active lesions often develop at the edge of atrophic areas, although they also may occur in entirely separate locations [11]. FA in the acute phase of the disease classically shows early hypofluorescence

In color fundus photographs, extensive bilateral areas of chorioretinal atrophy are evident, centered on the optic nerve, with a characteristic serpiginous or geographic pattern (A, B). On blue-light fundus autofluorescence (C, D), the affected areas appear hypoautofluorescent and are more prominent compared to color imaging due to the greater contrast with the preserved regions. The areas of activity are always at the margins of the lesion and typically appear hyperautofluorescent.
In color fundus photographs, extensive bilateral areas of chorioretinal atrophy are evident, centered on the optic nerve, with a characteristic serpiginous or geographic pattern (A, B). On blue-light fundus autofluorescence (C, D), the affected areas appear hypoautofluorescent and are more prominent compared to color imaging due to the greater contrast with the preserved regions. The areas of activity are always at the margins of the lesion and typically appear hyperautofluorescent.

Spectral-domain optical coherence tomography and fluorescein angiography reveal an active juxtafoveal superotemporal choroidal neovascularization (A), which regressed after intravitreal anti-VEGF therapy (B).
Spectral-domain optical coherence tomography and fluorescein angiography reveal an active juxtafoveal superotemporal choroidal neovascularization (A), which regressed after intravitreal anti-VEGF therapy (B).

Blue-light fundus autofluorescence reveals the progression of the atrophic area over a 10-year follow-up. The lower image shows spectral-domain optical coherence tomography from the 2017 follow-up, highlighting atrophy involving the outer retinal layers, retinal pigment epithelium, and choriocapillaris.
Blue-light fundus autofluorescence reveals the progression of the atrophic area over a 10-year follow-up. The lower image shows spectral-domain optical coherence tomography from the 2017 follow-up, highlighting atrophy involving the outer retinal layers, retinal pigment epithelium, and choriocapillaris.
of the placoid lesions due to edema of the outer retina and RPE and non-perfusion of the choriocapillaris, while in the later frames of the exam, the lesions become hyperfluorescent due to staining [12]. OCT scans show a thinning of the RPE due to the development of retinal atrophy with disruption of the photoreceptor layers and also cystic changes can be seen [13]. It is important to consider tuberculous serpiginous-like choroiditis in the differential diagnosis

Fundus photography (A) shows multiple yellow spots that appear hyperautofluorescent on Blue-Light Fundus Autofluorescence (B). Fluorescein angiography shows hyperfluorescent lesions with a ‘wreath-like’ pattern in the early phases (C), which progressively increase in intensity in the late phases (D). Indocyanine green angiography (E, F) shows multiple hypofluorescent lesions in the late phase, which are more numerous than those seen on fundus photography.
Fundus photography (A) shows multiple yellow spots that appear hyperautofluorescent on Blue-Light Fundus Autofluorescence (B). Fluorescein angiography shows hyperfluorescent lesions with a ‘wreath-like’ pattern in the early phases (C), which progressively increase in intensity in the late phases (D). Indocyanine green angiography (E, F) shows multiple hypofluorescent lesions in the late phase, which are more numerous than those seen on fundus photography.
and should be of particular concern in patients who present with serpiginous-like lesions and live in, or come from, areas with a high prevalence of tuberculosis. In contrast to SC, tuberculous serpiginous-like choroiditis tends to have significant vitritis and presents with multifocal lesions in both the posterior pole and periphery, often sparing the juxtapapillary area [14]. Acute episodes of inflammation are typically treated with high dose systemic steroids (e.g., oral prednisone, 60-80 mg/daily). Recurrences may occur when steroids are tapered, requiring the addition of immunosuppressive therapy [15]. CNV is a late complication in 25% of SC cases, often developing at the edge of chorioretinal atrophy, and may be treated with anti-VEGF injections [16] .
Multiple evanescent white dot syndrome
Multiple evanescent white dot syndrome (MEWDS) is an idiopathic inflammatory condition of the retina that typically presents with acute, unilateral (80%) blurred or decreased vision with central or peripheral scotoma in healthy young (10–47 years) and moderately myopic females (90%), frequently following a flu-like prodrome [17]. Funduscopy during the acute phase of the disease reveals multiple discrete white or yellow spots (100–200 μm) at the level of the

Spectral-domain optical coherence tomography reveals diffuse granularity at the level of the retinal pigment epithelium–Bruch’s membrane complex corresponding to the lesions, accompanied by alterations in the ellipsoid zone.
Spectral-domain optical coherence tomography reveals diffuse granularity at the level of the retinal pigment epithelium–Bruch’s membrane complex corresponding to the lesions, accompanied by alterations in the ellipsoid zone.

RPE or deep retina, typically in a perifoveal location. In some patients, transient foveal tiny yellow-orange flecks at the level of the RPE also develop; this is the classic hallmark of this condition. There may be few associated mild anterior chamber or vitreous cells, mild blurring of the optic disc, and in rare instances, isolated vascular sheathing [17]. FA shows early and late hyperfluorescence of the white dots in a wreath-like pattern [18]. ICG angiography shows multiple hypocianescent lesions that are more numerous than those seen on examination (with hypofluorescence around the optic nerve) or on fluorescein angiography, and that typically fade with resolution of the disease suggesting pathologic choroidal nonperfusion or RPE inflammation [19]. Visual field abnormalities are variable and include generalized depression, paracentral or peripheral scotoma, and enlargement of a blind spot and well-correlate with ICG angiography. Electroretinographic (ERG) alterations include reduced a-wave and early receptor potential amplitudes, both of which are reversible. The multifocal ERG and electro-oculogram (EOG) localize the disease process to the RPE/photoreceptor complex [20]. The spectral domain OCT images show subtle disruptions of the photoreceptor IS/OS junction in eyes with MEWDS. This may suggest that MEWDS is more likely associated with RPE inflammation. Swollen, but intact RPE cells appear normal on OCT imaging but the inflammation of the RPE cells could interrupt the orientation of photoreceptor outer segments acutely, causing attenuation of OCT signal from the IS/OS junction as the outer segments become misaligned [21]. The prognosis for MEWDS is excellent, with visual recovery occurring between two to ten weeks without treatment [15]
Punctate inner choroidopathy (PIC) is a disease that usually occurs in young (second to fourth decades of life) and myopic females [22]. It is usually characterized by unilateral or bilateral small, multifocal, yellow–white lesions in the inner choroid and RPE, located commonly in the macula region and around the optic nerve head, sometimes involving the peripheral retina [23] Common symptoms include decreased central vision, metamorphopsia, photopsias, paracentral, or temporal scotomas [24]. FA shows an early hypofluorescent area with a late staining in correspondence of the lesions seen on fundus examination [25]. ICG angiography reveals hypocianescent round spots that may be more numerous than seen on clinical examination and FA [26]. OCT performed through the lesions usually shows hyperreflective spots in the outer retina [27]. Blind spot enlargement on visual field examination is a classic manifestation of the

Color fundus photograph (A) shows yellowish infiltrates in the posterior pole, which appear hypoautofluorescent with a surrounding hyperautofluorescent halo on blue-light fundus autofluorescence (B).

Fluorescein angiography reveals early hypofluorescent areas (A) with late staining corresponding to the lesions. In this case, two active choroidal neovascularizations are also visible (B). On indocyanine green angiography (C, D), the areas of choroiditis appear as round hypocyanescent spots. Spectral-domain optical coherence tomography scans at the level of the neovascular lesions reveal hyperreflective subretinal areas (E, F).
Fluorescein angiography reveals early hypofluorescent areas (A) with late staining corresponding to the lesions. In this case, two active choroidal neovascularizations are also visible (B). On indocyanine green angiography (C, D), the areas of choroiditis appear as round hypocyanescent spots. Spectral-domain optical coherence tomography scans at the level of the neovascular lesions reveal hyperreflective subretinal areas (E, F).
PIC. Visual field tests may also reveal scotomas related to areas of photoreceptor decrease [28] The inflammation can be successfully managed with topical, intraocular, or systemic corticosteroids. However, the long-term visual prognosis is variabile, because most patients experience recurrences manifesting as vitreous haze, cystoid macular edema, subretinal scarring, or swelling. About one-third of patients may develop CNV, which can be treated with anti-VEGF injections or photodynamic therapy [29]
Birdshot Chorioretinopathy
Birdshot Chorioretinopathy (BCR), or vitiliginous chorioretinitis, is a rare, bilateral, chronic posterior uveitis that typically occurs in healthy patients in the fifth to seventh decade. Females are more affected than men. The link between BCR and HLA-A29 antigen expression has been firmly established. At the onset, patients complain of blurred vision or floaters. Lately, visual acuity impairment, nyctalopia, low contrast, and reduction in color sensitivity may occur [30,31]. Cystoid macular edema (CME) and retinal atrophy can, if untreated, result in decreased vision. Choroidal neovascular membranes may develop in 5% of eyes [32]. It has been described that symptoms can precede the onset of the fundus findings by several years [33]
Findings on examination include vitritis as well as multiple bilateral and symmetrical cream colored lesions posterior to equator at the level of the choroid [34]. FA often reveals delay in the appearance of dye in the retinal arterioles as well as profuse vascular leakage associated with an increase in retinal circulation time [35]. In the acute phase, birdshot lesions appear on ICG angiography as hypocianescent areas bordered by medium or large choroidal vessels in the intermediate phase. Late frame shows a diffuse choroidal hypercianescence [36]. OCT examination is useful to monitor the progression of CME and to reveal a significant thinning of the retina and choroid [37]. Visual field abnormalities include enlarged blind spot, central or paracentral scotomas, and generalized reduced sensitivity [38]. The treatment is based on the use of oral or intraocular corticosteroids with the aim to reduce inflammation and CME.
Steroid-sparing immunosuppressive medications are needed when steroids are not sufficient to control the disease [39]
Acute zonal occult outer retinopathy (AZOOR) is an inflammatory disorder that typically affects broad zones of the outer retina in one or both eyes in young women affected by myopia [40]. AZOOR was first described by Gass in 1992 with a report of 13 patients, mostly young women, with acute loss of zones of outer retinal function, photopsia, ERG changes, and minimal fundoscopic changes [40]. Since the first reports there have been more than 130 patients described in the literature. Some patients have a viral prodrome. Occasionally vitreous inflammation develops, notably in those with a large zone of visual field loss. The visual field usually stabilizes in 4-6 months and sometimes will improve. Although unilateral in presentation more than 60% of the time, there can be delayed involvement of the fellow eye. There can also be recurrences in the same eye. A variant of AZOOR, known as acute annular outer retinopathy (AAOR), was first described in 1994 by Luckie and Ai, et al, in which patients have an acute onset of scotoma [41]. This entity reveals a gray intraretinal ring at the edge of the scotoma. Gass proposed the pathogenesis to be related to an infection of the retinal photoreceptors adjacent to the optic nerve, likely from a viral source. He felt that the white dot syndromes were related entities that typically occur in young women with a similar constellation of findings. Jampol and Becker have presented an alternative theory with a common genetic hypothesis of autoimmune/inflammatory diseases. They hypothesize that there is an interplay of genetics, the immune system, and environmental triggers that lead to specific diseases such as AZOOR [42]. Common symptoms of patients with AZOOR are photopsias and visual field loss. Visual acuity is rarely affected. The funduscopic examination may appear normal or reveal mild vitritis [43]. OCT imaging shows disruption of the IS/OS junction in the region of the scotoma and occasionally loss of the outer nuclear layer [44]. The AZOOR line, which defines the transition from normal to involved retina, is best seen with fundus autofluorescence (FAF) which shows a classic “trizonal” pattern of autofluorescence: normal autofluorescence (zone 1), speckled hyperautofluorescence (zone 2), hypoautofluorescence (zone 3) [45,46]. FA and ICG exams may show angiographic changes in about 50% of patients, primarily related to changes in the RPE. Visual field examination shows scotomas, which can enlarge over time. Electroretinography is abnormal in the majority of AZOOR cases. Recently Mkrtchyan, Lujan, et al, reported on the outer retinal structure of AZOOR patients using adaptive optics scanning laser ophthalmoscopy (AOSLO). AOSLO can be used to generate high-resolution en-face images of the retina, which can show cone spacing in various locations. This group was able to demonstrate regions of cone loss, alteration in cone structure, as well as areas of normal cone mosaic in the region of visual loss [47]
Some patients completely recover from AZOOR, while others may experience permanent visual field defects related to the development of wide areas of RPE depigmentation or atrophy. There is no proven therapy. Systemic corticosteroids and other immunosuppressive drugs have shown poor results [48] .
Acute macular neuroretinopathy (AMN) is a condition described in 1975 by Bos and Deutman and characterized by an acute onset of paracentral scotomas in one or both eyes in young, otherwise healthy women [49,50]. The disease is believed to result from deep capillary ischemia of the macula region. The pathogenesis is still unknown, but could be linked to systemic viral infections. The fundoscopic examination reveals classic reddish-brown teardrop or

Infrared imaging shows distinctive hyporeflective areas. Spectral-domain optical coherence tomography highlights hyperreflective areas in the outer layers of the neurosensory retina, with disruption of the ellipsoid zone and interdigitation zone.
Infrared imaging shows distinctive hyporeflective areas. Spectral-domain optical coherence tomography highlights hyperreflective areas in the outer layers of the neurosensory retina, with disruption of the ellipsoid zone and interdigitation zone.
wedge-shaped lesions around the fovea [51]. These spots correspond exactly in shape, size, and location with the paracentral scotomas detected by the visual field exam. In some cases, lesions can be difficult to identify at slit-lamp examination, while they are easily detectable on near-infrared imaging. The OCT scans typically demonstrate an hyperreflectivity below the outer plexiform layer and the disruption of ellipsoid and interdigitation zones corresponding to the reddish lesions clinically seen [52, 53]. Usually, FA and ICG angiography are unremarkable [54, 55]. Multifocal ERG shows decreased foveal peaks in affected eyes [56]. The disease is self-limited and the lesions usually resolve over several weeks with a complete restoration of visual acuity and corresponding visual field defects. No treatment has been shown effective. Recently, Sarraf and colleagues described a retinal condition, paracentral acute middle maculopathy (PAMM), characterized by clinical features that resemble those seen in AMN. However, in comparison with AMN, PAMM is an OCT finding defined by the presence of a hyperreflective band at the level of the inner nuclear layer (INL) that indicates INL infarction caused by globally impaired perfusion through the retinal capillary system leading to hypoperfusion of the deep capillary plexus. Usually patients affected by PAMM are older males with good central vision, paracentral scotoma, and tend to have vascular risk factors [57]. Some reports proposed that in the acute phase, deep capillary ischemia could be differentiated from superficial capillary ischemia by the presence of mild deep retinal whitening on fundus photography with a relatively normal appearance on fluorescein angiography, mild thickening and hyperreflectivity of the middle retinal layers on OCT, slightly light appearance on red free imaging, and slight dark appearance on near infra-red imaging. In the chronic phase, thinning of the middle retinal layers may be the only indication of previous damage [58]
Spectral-domain optical coherence tomography shows a gradual reduction and subsequent disappearance of hyperreflective intraretinal areas over time.
Acute idiopathic maculopathy (AIM) is a condition characterized by an acute onset of unilateral vision loss between 15 and 45 years of age. No sex prediletion is reported. The etiology is still unknown, but it is often preceded by a flu-like illness. Examination findings included a solitary area of irregular yellow or gray RPE thickening involving the central macula, associated with serous retinal detachment and, in some instances, intraretinal hemorrhage. These alterations are typically central and unilateral, but recently the clinical spectrum of this disease entity has expanded to include bilateral cases as well as the presence of papillitis and an association with pregnancy and human immunodeficiency virus. FA may reveal irregular hyperfluorescence
of the subretinal thickening in the early phase and nearly complete hyperfluorescence in the late phase. OCT often reveals an exudative detachment of the macula and photoreceptors and RPE alterations, manifesting as a loss of the hyperreflective outer retinal bands. The pathophysiology of AIM likely involves an inflammation of the choroid, outer retina, and/or the RPE. An inflammatory origin of AIM is suggested by the occurrence, in many cases, of intraretinal hemorrhage and vitritis. The high incidence of an antecedent viral illness is indicative of an infectious etiology, which may, based on isolated case reports, represent coxsackievirus [59]
The natural history of AIM typically involves rapid and significant spontaneous improvement in visual acuity and clinical abnormalities, though a bull’s-eye pattern of RPE alteration has been described to persist [59]. In addition, recurrence is rare. Therefore, management of these patients should be conservative and consist of observation to ensure that resolution occurs as expected. Because AIM may be easily confused with other diagnoses, including CNV, it is extremely important to maintain a high index of suspicion for AIM in order to avoid unnecessary treatment.
Sarcoidosis associated posterior uveitis
Sarcoidosis is a chronic disorder of unknown origin, manifesting with systemic deposition of non-caseating granulomas that tend to affect lungs, skin, lymph nodes, eyes, central nervous system, reticulo-endothelial system, heart, and bones [60]. Ophthalmic involvement occurs in up to 50% of patients with systemic sarcoidosis, and is more common in women compared to men. Ocular involvement usually presents with blurry vision, floaters, photophobia, redness, and ocular discomfort [61]. Anterior uveitis is the most common manifestation, but cases of posterior uveitis with choroidal or retinal alterations have been described. Choroidal lesions are uncommon and largely variable in their features at the fundoscopic examination: multiple small pale-yellow infiltrates, often most numerous inferiorly, are the more common findings, while multiple large confluent infiltrates or solitary choroidal nodules are infrequent [62, 63]. In a few cases, retinal granulomas may also occur, manifesting as small creamy lesions. Periphlebitis may occur and appears as a yellow-white perivenous sheathing. Perivenous “candle wax drippings” exudates are suggestive of severe sarcoid periphlebitis [64]. Sometimes
Sarcoidosis associated posterior uveitis

Fundus photography shows multiple small, pale-yellow infiltrates (more evident in the right eye), predominantly located in the inferior region.

Fluorescein angiography highlights hyperfluorescent inflammatory retinal lesions in the periphery. Additionally, mild disc hyperfluorescence is observed in the right eye.
Fluorescein angiography highlights hyperfluorescent inflammatory retinal lesions in the periphery. Additionally, mild disc hyperfluorescence is observed in the right eye.

Indocyanine green angiography reveals peripheral choroidal lesions, which exhibit hypocyanescence. Indocyanine green angiography reveals peripheral choroidal lesions, which exhibit hypocyanescence.
optic nerve granulomas could be found, but do not usually affect vision. Persistent disc edema is a frequent finding in patients with vitreous or retinal involvement [65]. Multifocal choroiditis carries a guarded visual prognosis even after resolution, as a result of secondary choroidal neovascularization associated with macular or peripapillary chorioretinal scarring [66] . Systemic laboratory evaluation (tuberculin skin test, angiotensin converting enzyme serum levels, reactive C protein serum levels and erythrocyte sedimentation rate, calcemia, calciuria, alkaline phosphatase levels) and imaging studies (chest X-ray and high-resolution computer tomography) have to be carried out [67]. FA can show retinal vascular leakage, early blockage and late staining of choroidal granulomas, RPE window defects, and CME. Definitive diagnosis requires tissue biopsy showing non caseating granulomas. Sarcoidosis has been called the great imitator for its diverse profile of possible ocular manifestations. Seven ocular clinical signs were outlined [68]:
1) Mutton-fat KPs (large and small) and/or iris nodules at pupillary margin (Koeppe) or in stroma (Busacca);
2) Trabecular meshwork (TM) nodules and/or tent-shaped peripheral anterior synechiae (PAS);
3) Snowballs/string-of-pearl vitreous opacities;
4) Multiple chorioretinal peripheral lesions (active and atrophic);
5) Nodular and/or segmental periphlebitis (± candle-wax drippings) and/or macroaneurysm in an inflamedeye;
6) Optic disc nodule(s)/granuloma(s) and/or solitary choroidal nodule;
7) Bilaterality (assessed by clinical examination or investigational tests showing subclinical inflammation);
The International Workshop on Ocular Sarcoidosis recently defined the new diagnostic criteria for ocular sarcoidosis [69]:
• Definite ocular sarcoidosis: Niopsy-supported diagnosis with clinically corresponding uveitis.
• Presumed ocular sarcoidosis: Biopsy was not performed or negative. However, chest X-ray/ computer tomography findings with hilum changes and two positive listed intraocular findings.
• Probable ocular sarcoidosis: Biopsy was not performed or negative. No positive chest X-ray/ computer tomography findings, but three of the listed intraocular findings and two positive laboratory/imaging findings are available.
• Possible ocular sarcoidosis: Ocular sarcoidosis suspected intraocular findings or investigations without fitting into a pattern of the above categories.
Posterior uveitis generally requires systemic steroids or immunosuppressive agents such as methotrexate, azathioprine, cyclosporine, or antagonists of tumor necrosis factors such as adalimumab or infliximab [70, 71]. CME may respond to a topical NSAID or to intravitreal corticosteroids. Peripheral retinal neovascularization can be treated with scatter photocoagulation to ischaemic areas revealed by FA.
Vogt-Koyanagi-Harada Syndrome
Vogt-Koyanagi-Harada (VKH) syndrome is a bilateral autoimmune granulomatous uveitis associated with exudative retinal detachment and extraocular manifestations in the skin, meningeal, and auditory-vestibular involvement systems [72]. It is most common in the second to fourth decade of life, often in Latin American or Asian people [73]. The exact pathogenic mechanism of VKH is unknown. However, it is likely related to an autoimmune response directed against melanocyte antigens in genetically susceptible individuals. Certain HLA-DR4 loci have been associated with an increased risk of VKH. VKH is a bilateral disease; however, patients may present with unilateral findings, with the fellow eye becoming involved a few days later. Delays in involvement of the fellow eye from eleven months to six years later have been reported. Classically, VKH manifests in sequential stages: prodromal phase, acute uveitis, and chronic uveitis stages [74]. The prodromal stage is characterized by non-specific viral-like symptoms, which may include meningismus symptoms such as headaches, nausea, dizziness, and fever. The acute uveitic stage follows shortly thereafter, and patients typically complain of blurring vision and miodesopsias. At this stage, fundoscopic examination reveals classic signs of VKH, such as bilateral posterior choroidal thickening with serous retinal detachments, disc hyperemia, and RPE alterations [74]. Thickened choroid can also be detected by ultrasonography. FA studies often show multiple RPE leaks in the areas of serous retinal detachment, referred to as the “milky way” or “starry night” sign. Late staining of the optic nerve is often present [75]. ICG angiography usually shows early hypercianescence and multiple hypocianescent choroidal dots in the late frames [76]. OCT is useful to monitor the serous reti-
nal detachments in the acute uveitic stage [77]. Lumbar puncture is not necessary for the diagnosis of VKH disease with typical manifestations, but is useful if the patient presents atypical features to demonstrate cerebrospinal fluid pleocytosis [78]. The differential diagnosis of VKH disease includes sympathetic ophthalmia, uveal effusion syndrome, and posterior scleritis [79]. The chronic stage of the disease occurs weeks after the acute uveitic onset and is characterized by development of depigmentation of the choroid and skin vitiligo or poliosis [80]. The choroidal depigmentation usually produces a “sunset glow” fundus appearance. Recurrent posterior uveitis with exudative retinal detachment is uncommon, but acute episodic exacerbations of smoldering panuveitis with evident granulomatous anterior uveitis may occur. In the acute uveitic stage, aggressive systemic therapy is needed. High doses of corticosteroids are the first line treatment, with some patients requiring 100 mg of prednisone daily; a slow taper over three to six months is recommended [81]. Few patients may require additional immunomodulatory agents, such as cyclosporine or methotrexate. Recurrences do not respond as well to systemic corticosteroid treatment and usually require immunomodulatory agents [82]. A delay in diagnosis and treatment is associated with an increased risk of depigmentation of the skin and eye and an increased risk of cataract, glaucoma, and subretinal fibrosis. Nearly two-thirds of patients treated with early and aggressive systemic corticosteroid therapy retain 20/40 or better visual acuity [82]. CNV is a rare complication of chronic panuveitis and is responsible for severe visual acuity loss [83]
Choroidopathy in Systemic Lupus Erythematosus
Systemic lupus erythematosus (SLE) is a chronic multisystem autoimmune disease characterized by the production and deposition of pathologic autoimmune complexes and antibodies in several tissues. It is most common in the second to fifth decades of life, with a strong female preponderance (9:1). SLE has been linked to major histocompatibility complex genes HLA-A1,-B8,-D3, and-DQ, and to complement complexes C1q, C2, and C4. SLE can affect essentially all organs, and patients may present with a lot of non-specific complaints [84] The American College of Rheumatology (ACR) has established consensus criteria of which four or more should be present serially or simultaneously for the SLE diagnosis: malar rash, discoid rash, skin photosensitivity, oral ulcers, arthritis, serositis (pleuritis or pericarditis), renal disorders (nephritis or proteinuria), neurologic disorders (seizures or psychiatric alterations), hematologic disorders (anemia, leukopenia, lymphopenia, thrombocytopenia), antinuclear antibodies positivity, anti-DNA, anti-phospholipid, and anti-SM antibodies positivity [85]. Ophthalmic complications are common in SLE, affecting up to one-third of patients. The commonest complication is keratoconjunctivitis sicca (25% of SLE patients), while peripheral ulcerative keratitis is a rare but serious complication. Episcleritis is observed in 1–2% of the SLE cases. Scleritis is rare and may be anterior or posterior, necrotizing or non-necrotizing [86] Sometimes SLE causes orbital inflammation with acute proptosis, lid edema, conjunctival injection, chemosis, and IOP elevation [87]. Lupus retinopathy was first described by Bergmeister in 1929, and it may occur in 10% of SLE patients. It is usually bilateral but asymmetric. The classic clinical findings are cotton-wool spots, retinal hemorrhages, and vascular abnormalities (capillary dilation and venous dilation/tortuosity). Other signs may include retinal edema, hard exudates, and microaneurysms [88]. SLE related vaso-occlusive retinopathy is much less common but devastating because of subsequent neovascularization (up to 75%) that may be commonly complicated by vitreous hemorrhage (up to 63%), retinal traction and detachment (up to 27%). It is important to notice that mild retinopathy may be found incidentally, while vaso-occlusive retinopathy usually presents with reduced visual acuity, distortion, and large visual field loss. FA usually shows vascular staining or leakage in a patient with retinitis, while
capillary nonperfusion may be seen in ischemic disease [89]. Lupus choroidopathy is another potential ocular complication of SLE. Choroidopathy occurs with single or multiple serous detachments of the retina and RPE, which may be confused with idiopathic central serous chorioretinopathy (CSC). These serous detachments may extend over time but may reverse with control of the disease. FA and ICG angiography demonstrate typical CSC-like leakage from the choroid into the subretinal and sub-RPE spaces, and also reveal a variable degree of choroidal ischemia [90]. Finally, other rare SLE related ocular complications are ischemic optic neuropathy and acute optic neuritis [91]. In ocular SLE, the control of the systemic disease usually helps to improve the ophthalmic alterations. Mild SLE systemic cases can usually be treated with corticosteroid creams, short courses of NSAIDs, and hydroxychloroquine; while patients with more severe disease manifestations often require immunosuppressive agents, combined with systemic steroids. Additional local and regional therapies may be indicated, depending on the type of ocular alterations. Keratoconjunctivitis sicca may be treated with artificial tear supplementation, punctal occlusion, topical corticosteroids, or cyclosporine [92] . Episcleritis may be treated with topical NSAIDs or topical corticosteroids. Scleral, retinal and choroidal disease should be treated with systemic corticosteroids. Retinal vascular occlusions associated with antiphospholipid antibodies may be treated with the addition of warfarin or low-dose acetylsalicylic acid. Retinal neovascularization secondary to ischemic events usually requires a PRP treatment [90, 92]. Persistent vitreous hemorrhage or persistent retinal detachment may require vitreoretinal surgery. Generally, the visual prognosis is good with a prompt systemic and ocular disease treatment, but it could be very poor when severe complications like macular infarction or ischemic optic neuropathy occur [90] .
Sympathetic ophthalmia
Sympathetic ophthalmia (SO) is a bilateral granulomatous panuveitis that occurs after a penetrating ocular trauma or ocular surgery when the exciting eye incites inflammation both in the traumatized or operated eye as well as in the fellow (sympathizing) eye. The pathological process derives from the exposure of the immune system to sequestered uveal antigens and may occur days to decades after the initial insult [93]. The incidence can vary depending on the underlying injury, and has been reported as high as 0.2% to 0.5% after penetrating ocular injury [94]. Additionally, although SO can occur after any intraocular procedure, pars plana vitrectomy has been shown to be the leading surgical cause of SO, with an estimated risk of approximately 0.01% [95]. Patients often present with mild pain, photophobia, epiphora, and blurring of vision in the sympathizing eye. Anterior segment examination is variable, but classically exhibits conjunctival injection, granulomatous inflammation with mutton-fat keratic precipitates on the corneal endothelium, and flare. Iris synechiae or nodules may be present. Posterior segment findings include vitritis, retinal vasculitis, choroiditis, or papillitis [96]. Retinal edema or exudative detachment of the retina may also be present. Small yellow-white deposits, known as Dalen-Fuchs nodules, may be detected particularly in the midperiphery. Chronic SO can cause depigmentation of the choroid, leading to a “sunset-glow” fundus appearance similar to VKH (nummular chorioretinal lesions). In the acute phase, FA can either show early pinpoint hyperfluorescent leaks, believed to represent disruption of RPE cell junctions, or numerous hypofluorescent spots with pooling in the later phases, thought to be consistent with choroidal granulomas [97]. In the chronic phase, FA may exhibit window defects consistent with chorioretinal damage and atrophy, subretinal fibrosis, and/or CNV. ICG angiography most commonly shows multiple hypocyanescent spots or patches, which can attenuate or regress with treatment and are therefore good markers of disease activity. Ultrasound
imaging may be notable for choroidal thickening or exudative retinal detachment. On OCT imaging, serous detachments of the retina and thickening of the choroid can be seen in acute phases. Dalen-Fuchs nodules can also be seen as round hyperreflective lesions at the level of the outer retina disrupting the RPE [97]. It is a vision-threatening disease, although, with appropriate and timely diagnosis and treatment, a good visual outcome is possible. Complications include cataract and glaucoma. However, long-term visual acuity loss may result from chorio-retinal scars, development of CNV, or chronic macular edema [98]. The first line treatment is represented by high-dose oral corticosteroids (up to 2 mg/kg/day) with a slow tapering. Immunosuppressive drugs are requested in long term treatment. Topical corticosteroids and cycloplegics may be used to alleviate acute pain [99]. Intravitreal corticosteroids may also be used, especially in individuals who cannot tolerate systemic medications. The prevention of sympathetic ophthalmia entails careful microsurgical wound toilet and prompt closure of all penetrating injuries. Enucleation or evisceration of an injured eye to minimize risk of sympathetic ophthalmia should be undertaken within 14 days of the trauma only when the eye is blind (no light perception), painful, and structurally disorganized [96, 100]
References
1. Gass JD. Acute posterior multifocal placoid pigment epitheliopathy. Arch Ophthalmol. 1968;80(2):177–185.
2. Fiore T, Iaccheri B, Androudi S, et al. Acute posterior multifocal placoid pigment epitheliopathy: outcome and visual prognosis. Retina. 2009;29(7):994–1001.
3. Fitzpatrick PJ, Robertson DM. Acute posterior multifocal placoid pigment epitheliopathy. Arch Ophthalmol. 1973;89(5):373–376.
4. Dhaliwal RS, Maguire AM, Flower RW, et al. Acute posterior multifocal placoid pigment epitheliopathy: an indocyanine green angiographic study. Retina. 1993;13(4):317–325.
5. Montero JA, Ruiz-Moreno JM, Fernandez-Munoz M. Spectral domain optical coherence tomography findings in acute posterior multifocal placoid pigment epitheliopathy. Ocul Immunol Inflamm. 2011;19(1):48–50.
6. O’Halloran HS, Berger JR, Lee WB, et al. Acute multifocal placoid pigment epitheliopathy and central nervous system involvement: nine new cases and a review of the literature. Ophthalmology. 2001;108(5):861–868.
7. Lim WK, Buggage RR, Nussenblatt RB. Serpiginous choroiditis. Surv Ophthalmol. 2005;50(3):231–244.
8. Weiss H, Annesley WH, Shields JA, et al. The clinical course of serpiginous choroidopathy. Am J Ophthalmol. 1979;87(2):133–142.
9. Balarabe AH, Biswas J. Serpiginous choroiditis in a referral clinic in India: visual field changes and clinical correlates. Ocul Immunol Inflamm. 2014;22(5):379–383.
10. Laatikainen L, Erkkilä H. Serpiginous choroiditis. Br J Ophthalmol. 1974;58(9):777–783.
11. Hamilton AM, Bird AC. Geographical choroidopathy. Br J Ophthalmol. 1974;58(9):784–797.
12. Schatz HS, Maumenee AEM, Patz A. Geographic helicoid peripapillary choroidopathy: clinical presentation and fluorescein angiographic findings. Trans Am Acad Ophthalmol Otolaryngol. 1974;78:747–761.
13. Gallagher MJ, Yilmaz T, Cervantes-Castañeda RA, et al. The characteristic features of optical coherence tomography in posterior uveitis. Br J Ophthalmol. 2007;91(12):1680–1685.
14. Mackensen F, Becker MD, Wiehler U, et al. QuantiFERON TB-Gold – a new test strengthening long-suspected tuberculous involvement in serpiginous-like choroiditis. Am J Ophthalmol. 2008;146(5):761–766.
15. Hoyng C, Tilanus M, Deutman A. Atypical central lesions in serpiginous choroiditis treated with oral prednisone. Graefes Arch Clin Exp Ophthalmol. 1998;236(2):154–156.
16. Battaglia Parodi M, Iacono P, Verbraak FD, et al. Antivascular endothelial growth factors for inflammatory chorioretinal disorders. Dev Ophthalmol. 2010;46:84–95.
17. Jampol LM, Sieving PA, Pugh D, et al. Multiple evanescent white dot syndrome. I. Clinical findings. Arch Ophthalmol. 1984;102(5):671–674.
18. Marsiglia M, Gallego-Pinazo R, Cunha de Souza E, et al. Expanded clinical spectrum of multiple evanescent white dot syndrome with multimodal imaging. Retina. 2016;36(1):64–74.
19. Ie D, Glaser BM, Murphy RP, et al. Indocyanine green angiography in multiple evanescent white-dot syndrome. Am J Ophthalmol. 1994;117(1):7–12.
20. Sieving PA, Fishman GA, Jampol LM, et al. Multiple evanescent white dot syndrome. II. Electrophysiology of the photoreceptors during retinal pigment epithelial disease. Arch Ophthalmol. 1984;102(5):675–679.
21. Sikorski BL, Wojtkowski M, Kaluzny JJ, et al. Correlation of spectral optical coherence tomography with fluorescein and indocyanine green angiography in multiple evanescent white dot syndrome. Br J Ophthalmol. 2008;92(11):1552–1557.
22. Watzke RC, Packer AJ, Folk JC, et al. Punctate inner choroidopathy. Am J Ophthalmol. 1984;98(5):572–584.
23. Essex RW, Wong J, Fraser-Bell S, et al. Punctate inner choroidopathy: clinical features and outcomes. Arch Ophthalmol. 2010;128(8):982–987.
24. Gerstenblith AT, Thorne JE, Sobrin L, et al. Punctate inner choroidopathy: a survey analysis of 77 persons. Ophthalmology. 2007;114(6):1201–1204.
25. Morgan CM, Schatz H. Recurrent multifocal choroiditis. Ophthalmology. 1986;93(9):1138–1147.
26. Vadalà M, Lodato G, Cillino S. Multifocal choroiditis: indocyanine green angiographic features. Ophthalmologica. 2001;215(1):16–21.
27. Vance SK, Khan S, Klancnik JM, et al. Characteristic spectral-domain optical coherence tomography findings of multifocal choroiditis. Retina. 2011;31(4):717–723.
28. Khorram KD, Jampol LM, Rosenberg MA. Blind spot enlargement as a manifestation of multifocal choroiditis. Arch Ophthalmol. 1991;109(10):1403–1407.
29. Uparkar M, Borse N, Kaul S, et al. Photodynamic therapy following intravitreal bevacizumab in multifocal choroiditis. Int Ophthalmol. 2008;28(5):375–377.
30. Shah KH, Levinson RD, Yu F, et al. Birdshot chorioretinopathy. Surv Ophthalmol. 2005;50(6):519–541.
31. Ladas JG, Arnold AC, Holland GN. Control of visual symptoms in two men with birdshot retinochoroidopathy using low-dose oral corticosteroid therapy. Am J Ophthalmol. 1999;128(1):116–118.
32. Soubrane G, Coscas G, Binaghi M, et al. Birdshot retinochoroidopathy and subretinal new vessels. Br J Ophthalmol. 1983;67(7):461–467.
33. Soubrane G, Bokobza R, Coscas G. Late developing lesions in birdshot retinochoroidopathy. Am J Ophthalmol. 1990;109(2):204–210.
34. Gasch AT, Smith JA, Whitcup SM. Birdshot retinochoroidopathy. Br J Ophthalmol. 1999;83(2):241–249.
35. Priem HA, Oosterhuis JA. Birdshot chorioretinopathy: clinical characteristics and evolution. Br J Ophthalmol. 1988;72(9):646–659.
36. Fardeau C, Herbort CP, Kullmann N, et al. Indocyanine green angiography in birdshot chorioretinopathy. Ophthalmology. 1999;106(10):1928–1934.
37. Young M, Fallah N, Forooghian F. Choroidal degeneration in birdshot chorioretinopathy. Retina. 2015;35(4):798–802.
38. Fuerst DJ, Tessler HH, Fishman GA, et al. Birdshot retinochoroidopathy. Arch Ophthalmol. 1984;102(2):214–219.
39. Menezo V, Taylor SR. Birdshot uveitis: current and emerging treatment options. Clin Ophthalmol. 2014;8:73–81.
40. Gass JD. Acute zonal occult outer retinopathy. Donders Lecture: The Netherlands Ophthalmological Society, Maastricht, Holland, June 19, 1992. J Clin Neuroophthalmol. 1993;13(2):79–97.
41. Luckie A, Ai E, Del Piero E. Progressive zonal outer retinitis. Am J Ophthalmol. 1994; 118: 583-588.
42. Jampol LM, Becker KG. White spot syndromes of the retina: a hypothesis based on the common genetic hypothesis of autoimmune/inflammatory disease. Am J Ophthalmol. 2003; 135: 379-379.
43. Mrejen S, Khan S, Gallego-Pinazo R, et al. Acute zonal occult outer retinopathy: a classification based on multimodal imaging. JAMA Ophthalmol. 2014;132(9):1089– 1098.
44. Fujiwara T, Imamura Y, Giovinazzo VJ, et al. Fundus autofluorescence and optical coherence tomographic findings in acute zonal occult outer retinopathy. Retina. 2010;30(8):1206–1216.
45. Spaide RF. Collateral damage in acute zonal occult outer retinopathy. Am J Ophthalmol. 2004;138(5):887–889.
46. Spaide RF, Koizumi H, Freund KB. Photoreceptor outer segment abnormalities as a cause of blind spot enlargement in acute zonal occult outer retinopathy-complex diseases. Am J Ophthalmol. 2008;146(1):111–120.
47. Mkrtchyan M, Lujan BJ, Merino D, Thirkill CE, Roorda A, Duncan JL. Outer retinal structure in patients with acute zonal occult outer retinopathy. Am J Ophthalmol. 2012;153(4):757-768.
48. Chen SN, Yang CH, Yang CM. Systemic corticosteroids therapy in the management of acute zonal occult outer retinopathy. J Ophthalmol. 2015;2015:793026.
49. Bos PJ, Deutman AF. Acute macular neuroretinopathy. Am J Ophthalmol. 1975;80(4):573–584.
50. Turbeville SD, Cowan LD, Gass JD. Acute macular neuroretinopathy: a review of the literature. Surv Ophthalmol. 2003;48(1):1–11.
51. Miller MH, Spalton DJ, Fitzke FW, et al. Acute macular neuroretinopathy. Ophthalmology. 1989;96(2):265–269.
52. Yeh S, Hwang TS, Weleber RG, et al. Acute macular outer retinopathy (AMOR): a reappraisal of acute macular neuroretinopathy using multimodality diagnostic testing. Arch Ophthalmol. 2011;129(3):365–368.
53. Vance SK, Spaide RF, Freund KB, et al. Outer retinal abnormalities in acute macular neuroretinopathy. Retina. 2011;31(3):441–445.
54. Bos PJ, Deutman AF. Acute macular neuroretinopathy. Am J Ophthalmol. 1975;80(4):573–584.
55. Abu el-Asrar AM. Serpiginous (geographical) choroiditis. Int Ophthalmol Clin. 1995;35(2):87–91.
56. Maschi C, Schneider-Lise B, Paoli V, et al. Acute macular neuroretinopathy: contribution of spectral-domain optical coherence tomography and multifocal ERG. Graefes Arch Clin Exp Ophthalmol. 2011;249(6):827–831.
57. Rahimy E, Sarraf D. Paracentral acute middle maculopathy spectral-domain optical coherence tomography feature of deep capillary ischemia. Curr Opin Ophthalmol. 2014;25(3):207–212.
58. Tsui I, Sarraf D: Paracentral acute middle maculopathy and acute macular neuroretinopathy. Ophthalmic Surg Lasers Imaging Retina. 2013;44:S33-35.
59. Yannuzzi LA, Jampol LM, Rabb MF, Sorenson JA, Beyrer C, Wilcox LM Jr. Unilateral acute idiopathic maculopathy. Arch Ophthalmol. 1991;109(10):1411–1416.
60. Baughman P, eirs ein AS, Judson MA, e al. Case Con rol Etiologic Study on Sarcoidosis (ACCESS) research group. Clinical characteristics of patients in a case control study of sarcoidosis. Am JRespir Cri Care Med.2001;164(10P 1):1885–1889.
61. Jamilloux Y, Kodjikian L, Broussolle C, et al. Sarcoidosis and uveitis. Autoimmun Rev. 2014;13:840–849.
62. Karma A. Ophthalmic changes in sarcoidosis. Acta Ophthalmol Suppl. 1979;1–94.
63. Sanders MD, Shilling JS. Retinal, choroidal, and optic disc involvement in sarcoidosis. Trans Ophthalmol Soc U K. 1976;96:140–144.
64. Jones N, Mochizuki M. Sarcoidosis: epidemiology and clinical features. Ocul Immunol Inflamm. 2010;18(2):72–79.
65. Blain JG, Riley W, Logothetis J. Optic nerve manifestations of sarcoidosis. Arch Neurol. 1965;13:307–309.
66. Lobo A, Bar on K, Minassian D, e al. Visual loss in sarcoid-related uveitis. Clin Experiment Ophthalmol. 2003;31(4):310–316.
67. Nussenblat B and Whi cup SM. Uvei is: Fundamentals and Clinical Practice. Philadelphia: Mosby; 2010: 278–288.
68. Herbor CP, ao NA, Mochizuki M. International criteria for the diagnosis of ocular sarcoidosis: results of the first International Workshop on Ocular Sarcoidosis (IWOS). Ocul Immunol Inf amm. 2009;17(3):160–169.
69. Yang SJ, Salek S, Rosenbaum JT. Ocular sarcoidosis: new diagnostic modalities and treatment. Curr Opin Pulm Med. 2017;23(5):458-467.
70. Mathur A, Kremer JM. Immunopathology, rheumatic features, and therapy of sarcoidosis. Curr Opin Rheumatol. 1992;4:76–80.
71. Muller-Quernheim J, Kienast K, Held M, et al. Treatment of chronic sarcoidosis with an azathioprine/prednisolone regimen. Eur Respir J. 1999;14:1117–1122.
72. Moorthy RS, Inomata H, Rao NA. Vogt–Koyanagi–Harada syndrome. Surv Ophthalmol. 1995;39:265–292.
73. Goto H, Mochizuki M, Yamaki S, et al. Epidemiological survey of intraocular inflammation in Japan. Jpn J Ophthalmol. 2007;51:41–44.
74. Read RW, Holland GN, Rao NA, et al. Revised diagnostic criteria for Vogt–Koyanagi–Harada disease: report of an international committee on nomenclature. Am J Ophthalmol. 2001;131:647–652.
75. Baltmr A, Lightman S, Tomkins-Netzer O. Vogt-Koyanagi-Harada syndrome - current perspectives. Clin Ophthalmol. 2016. 10:2345-2361.
76. Miyanaga M, Kawaguchi T, Miyata K, et al. Indocyanine green angiography findings in initial acute pretreatment Vogt–Koyanagi–Harada disease in Japanese patients. Jpn J Ophthalmol. 2010;54:377–382.
77. Yamaguchi Y, Otani T, Kishi S. Tomographic features of serous retinal detachment with multilobular dye pooling in acute Vogt–Koyanagi–Harada disease. Am J Ophthalmol. 2007;144:260–265.
78. Tsai JH, Sukavatcharin S, Rao NA. Utility of lumbar puncture in diagnosis of Vogt–Koyanagi–Harada disease. Int Ophthalmol. 2007;27:189–194.
79. Rao NA, Marak GE. Sympathetic ophthalmia simulating Vogt–Koyanagi–Harada’s disease: a clinico-pathologic study of four cases. Jpn J Ophthalmol. 1983;27:506–511.
80. Moorthy RS, Chong LP, Smith RE, et al. Subretinal neovascular membranes in Vogt–Koyanagi–Harada syndrome. Am J Ophthalmol. 1993;116:164–170.
81. Rubsamen PE, Gass JDM. Vogt–Koyanagi–Harada syndrome. Clinical course, therapy, and long-term visual outcome. Arch Ophthalmol. 1991;109:682–687.
82. Bykhovskaya I, Thorne JE, Kempen JH, et al. Vogt– Koyanagi–Harada disease: clinical outcomes. Am J Ophthalmol. 2005;140:674–678.
83. Read RW, Rechodouni A, Butani N, et al. Complications and prognostic factors in Vogt–Koyanagi–Harada disease. Am J Ophthalmol. 2001;131:599–606.
84. Smith PP, Gordon C. Systemic lupus erythematosus: clinical presentations. Autoimmun Rev. 2010;10:43–45.
85. Hochberg MC. Updating the American College of Rheumatology revised criteria for the classification of systemic lupus erythematosus. Arthritis Rheum. 1997;40:1725.
86. Read RW. Clinical mini-review: systemic lupus erythematosus and the eye. Ocul Immunol Inflamm. 2004;12:87–99.
87. Stavrou P, Murray PI, Batta K, et al. Acute ocular ischaemia and orbital inflammation associated with systemic lupus erythematosus. Br J Ophthalmol. 2002;86:474–475.
88. Ushiyama O, Ushiyama K, Koarada S, et al. Retinal disease in patients with systemic lupus erythematosus. Ann Rheum Dis. 2000;59:705–708.
89. Jabs DA, Fine SL, Hochberg MC, et al. Severe retinal vaso- occlusive disease in systemic lupus erythematosus. Arch Ophthalmol. 1986;104:558–563.
90. Jabs DA, Hanneken AM, Schachat AP, et al. Choroidopathy in systemic lupus erythematosus. Arch Ophthalmol. 1988;106:230–234.
91. Jabs DA, Miller NR, Newman SA, et al. Optic neuropathy in systemic lupus erythematosus. Arch Ophthalmol. 1986;104:564–568.
92. Sivaraj RR, Durrani OM, Denniston AK, et al. Ocular manifestations of systemic lupus erythematosus. Rheumatology (Oxford). 2007;46:1757–1762.
93. Duke-Elder S. Sympathetic ophthalmitis. Mosby: St. Louis; 1966:558–593. Duke-Elder S. System of ophthalmology. vol. 9.
94. Vote BJ, Hall A, Cairns J, et al. Changing trends in sympathetic ophthalmia. Clin Experiment Ophthalmol. 2004;32:542–545.
95. Arevalo JF, Garcia RA, Al-Dhibi HA, Sanchez JG, Suarez-Tata L. Update on sympathetic ophthalmia. Middle East AFr J Ophthalmol. 2012. 19(1):13-21.
96. Castiblanco CP, Adelman RA. Sympathetic ophthalmia. Graefes Arch Clin Exp Ophthalmol. 2009;247:289–302.
97. Mahajan S, Invernizzi A, Agrawal R, Biswas J, Rao NA, Gupta V. Multimodal imaging in sympathetic ophthalmia. Ocul Immunol Inflamm. 2017; 25(2): 152-159.
98. Makley TA Jr, Azar A. Sympathetic ophthalmia: a long-term follow-up. Arch Ophthalmol. 1978;96:257–262.
99. Jabs DA, Rosenbaum JT, Foster CS, et al. Guidelines for the use of immunosuppressive drugs in patients with ocular inflammatory disorders: recommendations of an expert panel. Am J Ophthalmol. 2000;130:492–513.
100. Lubin JR, Albert DM, Weinstein M. Sixty-five years of sympathetic ophthalmia: a clinicopathologic review of 105 cases (1913–1978). Ophthalmology. 1980;87:109–121.
Gianni Virgili, Daniela Bacherini, Lorenzo Vannozzi, Ludovica Alonzo, Lorenzo Cifarelli, Francesco Dragotto, Fabrizio Giansanti
Necrotizing Herpetic Retinitis
Herpesviridae is a large family of DNA viruses that can cause infections and certain diseases in humans, including necrotizing retinitis. Five species of herpesviruses are known to cause ocular inflammation: Herpes Simplex 1 and 2 (HSV-1, HSV-2), Varicella Zoster Virus (VZV), Cytomegalovirus (CMV) and Epstein-Barr virus (EBV).
Necrotizing herpetic retinitis defines a spectrum of potentially devastating, rapidly progressive viral retinopathies secondary to herpes viruses, specifically HSV-1 and HSV-2, VZV, and CMV. In necrotizing viral retinitis the virus infects retinal cells and causes necrosis from virally induced cytolysis and vascular occlusion [1]
Acute retinal necrosis (ARN)
Acute retinal necrosis (ARN) is an uncommon but serious syndrome most often caused by the VZV, but also by HSV-1 or HSV-2, CMV or rarely EBV. It was first described in 1971 by Urayama and colleagues as an acute panuveitis with retinal periarteritis progressing to diffuse necrotizing retinitis and retinal detachment [2]. Non-necrotizing and multifocal posterior necrotizing variants also have been described. The patients are more often immunocompetent, males are slightly predilected, and it typically affects people aged 20–60 [3]. They usually report ocular pain, photophobia, redness, blurred vision, and floaters [4]
Clinical characteristics include:
1. one or more well-demarcated foci of retinal necrosis in the peripheral retina (areas of retinal whitening/necrosis). (Figure 1)
2. rapid posterior progression or development of new foci (within days to weeks) in the absence of antiviral therapy.
3. circumferential spread of necrosis (from periphery to the macula)
4. occlusive vasculopathy with arterial involvement (arteriole narrowing and sheathing of large retinal vessels, scattered hemorrhages)
5. a prominent inflammatory reaction in the vitreous (cell and haze) and anterior chamber (including conjunctival injection, fine or granulomatous keratic precipitates and anterior chamber cells) [5,6]
Frequent complications are full thickness retinal holes in the affected areas that become thin and atrophic, and retinal detachment, both rhegmatogenous and tractional in nature, in up to 80% of cases [7] .
Progressive outer retinal necrosis (PORN)
Progressive outer retinal necrosis (PORN) is a clinical variant of necrotizing herpetic retinopathy caused by the VZV. It’s seen exclusively in immunocompromised patients, more often with

Figure 1. ARN: retinitis with well-demarcated borders, whitening of the retina, occlusive retinal vasculitis, and vitritis. Note the absence of retinal hemorrhage that is characteristic of the lesions.
the acquired immunodeficiency syndrome (AIDS). The aetiology is similar to ARN, involving reactivation of a latent herpes infection. However, differently from the previous syndrome, the inflammatory reaction is minimal or absent, despite extensive retinal involvement (particularly the deep retina) with a progression to necrosis that is drastically rapid, from the posterior pole to the peripheral retina. Fundus exam shows areas of multifocal retinal necrosis with opacification in the outer retina [8]. Retinal vasculitis is not characteristic of PORN. Patients initially present with painless disturbance in peripheral vision in one or both eyes. Without therapy, the necrosis rapidly progresses to involve the entire retina in a circumferen-
Symptoms
Clinical features
Immune status
Focus and spatial progression
Eye pain
Redness
Decreased peripheral vision
Floaters
Photopobia
Pheripheral retinal whitening
Vitritis
Vasculitis
Both immunocompetent (+++) and immunocompromised
Multifocal
Circumferential from periphery
Painless
Drastic decreased vision
Multifocal deep retinal white lesions that become confluent
Early posterior pole involvement
Immunocompromised
Multifocal Central and non-specific
Painless
Decreased peripheral or central vision
May be asymptomatic
Perivascular retinitis
Hemorrhages
Granular borders
Immunocompromised
Single focus
Perivascular
Vasculitis Yes No Variable
Intraocular inflammation
Common (Vitritis+++) Uncommon
Less common
Progression Rapid Rapid Slow
Table 1. Clinical features of necrotizing herpetic retinitis
tial fashion, and the visual prognosis is very poor, with nearly two-thirds of eyes with the disease progressed to no light perception (NLP) within 4 weeks of onset [9]. Retinal detachments frequently occur secondary to thin necrotic retina.
Ocular CMV infection may manifest as anterior uveitis, corneal endothelitis, or as the potentially blinding chorioretinitis. The retinitis is typically seen in immunocompromised hosts, occurring in neonates, bone marrow and solid organ transplant recipients (mostly CMV-negative individuals who receive organs from CMV-positive donors), and persons with acquired immunodeficiency syndrome (AIDS) from the human immunodeficiency virus (HIV). More rarely, CMV retinitis occurs in individuals with malignancy or primary immunodeficiencies, or patients who underwent systemic immunosuppressive therapy and intravitreal corticosteroid injections or steroid implants for diabetic retinopathy, uveitis, and vein occlusions. Histologically, CMV retinitis appears as areas of full-thickness retinal necrosis and edema or exudative detachment. Clinically, CMVR can be asymptomatic or present with decreased visual acuity. Vitritis is usually absent. Significant visual impairment is caused by retinal necrosis involving the macula or optic nerve. Vision loss or blindness may also occur as a result of CMVR complications, such as retinal detachment, cataract formation, or epiretinal membrane.
Several ophthalmoscopic patterns of CMVR are described. There are three main presentations:
• hemorrhagic retinitis within the posterior pole distributed along retinal vasculature, in which wedge-shaped areas of whitening are associated with hemorrhage (brush-fire)
• a granular, indolent form with active retinitis at borders of the lesion, with variable small dot-like lesion
• more rarely, retinal vasculitis with perivascular sheathing (an atypical manifestation with clinical appearance similar to frosted branch angiitis) CMVR typically begins in the peripheral retina (mostly perivascular) and progresses centripetally toward the posterior pole, but the progression is slower than necrotizing retinopathies caused by HSV and VZV [10,11,12]. (Figure 2)

Although clinical syndromes are quite typical, polymerase chain reaction (PCR) of the vitreous and aqueous specimens is sensitive and specific for confirming the causative viral agent. Also, IgM and IgG for herpetic viruses can be tested in the aqueous humour and the ratio with serum levels (Goldmann Witmer coefficient).
Imaging
Fluorescein (FA) and indocyanine green (ICG) angiography is typically not necessary for diagnosis and management of the necrotizing retinitis, and has limited utility in cases with severe vitritis, but it can be helpful in delineating the extent of disease, highlighting vascular abnormalities such as enlarged foveal avascular zone, microaneurysms, hypofluorescence in areas of retinal oedema and vascular leakage in areas of inflammation during active disease [14] Swept Source (SS) OCT and Spectral Domain (SD) OCT both show areas of retinal whitening, acutely, as highly reflective inner retina lesions with obscuration of the retinal architecture [15] . They could be associated to macular edema and exudates at the posterior pole and areas of peripheral retinitis with findings of full thickness retinal hyperreflectivity and intraretinal and subretinal cysts [16]. With initiation of antiviral treatment and normalization of the retina appearance clinically, OCT shows marked retinal thinning with disruption of retinal architecture and choroid hyperreflectivity secondary to RPE atrophy. In patients with macular disease at presentation, the ellipsoid layer did not recover, despite disease regression and visual acuity remained poor. OCT indirect findings of inflammation are retinal traction and eventual development of combination tractional/rhegmatogenous detachment.
Fundus autofluorescence (FAF) imaging is useful because autofluorescence is thought to precede the photoreceptor degeneration. Mottled regions of hyper- and hypo-autofluorescence corresponded to either RPE atrophy or various stages of healing.
FAF and ultrawide-field fundus imaging (UWF), which captures approximately 200° of the retina, have been most recently used to monitor disease progression in herpetic retinitis [17,18]
Management
Treatment should not be withheld while awaiting PCR test results.
• ARN-PORN
Treatment should be initiated early with the objective of hastening the resolution of disease in the infected eye and preventing contralateral disease. Patients should be hospitalized and treated with a 10 to 14-day course of intravenously administered acyclovir 10 to 15 mg/kg every 8 hours, followed by oral acyclovir 800 mg five times a day for 6 to 12 weeks [19]
Recently, outpatient treatment with orally administered valacyclovir at 2 g TID has been shown to achieve systemic levels similar to intravenous acyclovir [20,21]
Local treatment with intravitreal injections of ganciclovir (2 mg/0.1 mL) is effective in treating sight-threatening herpetic infections with fovea or optic disc involvement. Patients receiving combination systemic and intravitreal antiviral therapy are more likely to have improvement in visual acuity and lower incidence of retinal detachment than those treated with systemic therapy alone [22]
Oral steroids in ARN should be administered under antiviral cover, starting 24 to 48 hours after antiviral therapy, particularly in cases with optic nerve involvement. They should not be used in patients with PORN.
The role of prophylactic laser posterior to the area of active retinitis to prevent RD in the setting of recent ARN still stands doubtful. Early vitrectomy for retinal detachments in ARN can be crucial and can lead to a possible benefit in terms of reducing the frequency of RD, but all
studies are limited by unbalanced baseline characteristics, variable follow-up time, and lack of a visual benefit. Many patients require more than one surgery, because of high chances of redetachment due to increased risk of proliferative vitreoretinopathy (PVR), and visual acuity may remain poor after surgery despite successful reattachment [23] • CMVR
First-line treatment of CMV retinitis is usually oral valganciclovir (900 mg twice daily during induction therapy, followed by 900 mg daily for maintenance), which is a prodrug of ganciclovir with higher bioavailability. Currently available therapies also include intravenous and intravitreal ganciclovir (induction therapy is given at 5 mg/kg every 12 hours for 14 to21 days followed by a maintenance dose of 5 mg/kg/day) and foscarnet, and intravenous cidofovir. The cause of immunocompromise should be treated adequately [24]
The principal side effect of ganciclovir and valganciclovir is myelosuppression; hence blood counts monitoring needs to be done. In patients with immediately sight-threatening lesions (lesions close to the macula or optic nerve head), local therapy with intravitreal injection of ganciclovir (2 mg/0.1 ml) or foscarnet (2.4 mg or 1.2 mg /0.1 ml) with concurrent systemic therapy can be given. They act for 6 to 8 months and have a low-risk profile; however, they do not afford any protection for the fellow eye or other visceral involvement.
Coxsackievirus may cause infectious diseases of the retina and pigment epithelium with predilection for the central macula. Unilateral acute idiopathic maculopathy (UAIM) is a rare inflammatory process involving the outer retina and retinal pigment epithelium (RPE) of the macula [25]. It affects healthy young adults. Patients present with sudden central vision loss, usually in one eye. Symptoms often follow a viral prodrome, presumed to be coxsackievirus, which causes hand-foot-and-mouth disease. During the acute phase, a serous neurosensory detachment overlying a greyish plaque at the level of the RPE is seen (Figure 3), often eccentric to the fovea and is sometimes associated with papillitis, subretinal exudation, intraretinal hemorrhages, and/or vitreous cells [26]

FA shows rapid and severe subretinal leakage. Most cases resolve spontaneously over several weeks with near complete recovery of vision. Following resolution of the acute phase, patients commonly demonstrate a “bull’s-eye” appearance to the macula at the site of the acute placoid subretinal inflammatory lesion. The concentric or “bull’s-eye” pattern of atrophy corresponds to the previous macular detachment.
Coronavirus disease-2019 (COVID-19) is caused by the most recently discovered coronavirus SARS-CoV-2, and is associated with adult respiratory distress syndrome (ARDS) and different systemic manifestations. SARS-CoV-2 is able to infect endothelial cells [27] and has been detected in the retina [28]. An involvement of the retinal vasculature, particularly veins, has been described. Retinal findings in COVID-19 included: hemorrhages, cotton wools spots, dilated veins, tortuous vessel [29]. (Figure 4)

Figure 4. Retinal findings in patients with COVID-19 ARDS intubated in an ICU. (A) Color fundus photograph showing two cotton wool spots at the inferior retinal arcade. (B) Red-free imaging showing arteriolar saccular dilatation on an arteriovenous shunt area (IRMA). (C) Colour fundus photograph showing a peripheral cockade hemorrhage related to an IRMA area and a microhemorrhage. (D) Color fundus photograph showing a flameshaped hemorrhage at the mid-periphery. From [30]
Syphilis
Syphilis is a sexually transmitted or congenital disease caused by the spirochete Treponema pallidum with several clinical presentations in various districts; its wide variety of manifestation gave it the name “the great imitator.” The natural history of acquired syphilis is divided in four stages: primary syphilis appears with the characteristic syphiloma, an erythematous papule at the inoculation site that progressively erodes forming a painless chancre, 1 to 3 months after the contamination. Secondary syphilis shows in 4-10 weeks and is characterized by a generalized maculopapular or pustular rash on hands, feet or trunk, joint and muscle pain, fever and headache, sings that tend to resolve in almost all patients. Latent syphilis has serological evidence of disease without active symptoms; it is subdivided in early (potential symptoms relapse) or late latent syphilis, with a cut-off of 2 years after exposure according to WHO. Tertiary syphilis determines neurological, cardiovascular, or gummatous damage (a chronic granulomatous lesion of the skin).
Congenital syphilis is characterized by the Hutchinson triad that consists in Hutchinson’s teeth, interstitial keratitis, and sensorineural deafness [31,32,33]
Syphilis is often known as “the great imitator” and the differential diagnosis of ocular syphilis is particularly challenging, as it presents similarly to other ocular conditions, such as acute retinal necrosis, and it can mimic many other causes of uveitis. Ocular involvement can occur at almost any phase and it can affect any tissue of the eye. In addition, it is not always simultaneous with systemic signs. Symptoms include decreased vision, floaters, photopsias, redness, and pain [34]. Conjunctivitis, episcleritis, and scleritis have been reported during secondary and tertiary syphilis; in the pre-antibiotic era, interstitial keratitis was associated with congenital syphilis. Anterior uveitis is typically unilateral, granulomatous or non-granulomatous, and is usually associated with raised intraocular pressure (and is a frequent cause of inflammatory ocular hypertension syndrome) [35]. Iris roseolae (vessel dilations in the internal third of the iris) are typical but uncommon [36]. Posterior uveitis is also typical of secondary syphilis, and varies widely in presentation: during active phases, uveitis is typically florid, with retinochoroiditis the most frequent presentation. But other clinical findings are neuroretinitis, chorioretinitis, and necrotizing retinitis, also called syphilitic retinal necrosis (SRN), which is characterized by multifocal, coalescent whitish lesions with a mottled and typical ground glass retinitis, shallow serous retinal detachment, vitritis, and small round vitreous opacities [37]. (Figure 9) It usually starts from the posterior pole and can be accompanied by creamy yellow pre-retinal lesions, which are probably collections of white cells [38]. Retinal vasculitis involving both arteries and veins, with occlusive consequences, is another manifestation of posterior uveitis. Optic disc can appear pale or oedematous. Acute posterior placoid chorioretinopathy (APPC) is frequent in secondary and late latent syphilis and is characterized by large yellowish placoid retinochoroidal lesions in the macular and juxtapapillary region, with typical OCT signs like disruption of the ellipsoid layer, hyperreflective thickening, irregularity and nodularity of RPE, subretinal fluid in early phases, and punctate choroid hyperreflectivity [39,40]. (Figures 5, 6) Neuro-ophthalmic symptoms are frequent during neurological involvement and the most frequent signs are Argyll Robertson pupils (absence of pupillary reflex, presence of accommodation reflex) and optic disc atrophy [41,42] Diagnosis is based on:
- Complete ophthalmological examination (including pupillary reflex);
- OCT: disruption of the ellipsoid layer, RPE nodular thickening, subretinal fluid, and punctate hyperreflectivity of the choroid;


Figure 5. Posterior Placoid Maculopathy: characterized by large yellowish placoid retinochoroidal lesions in the macular and juxtapapillary region.


Figure 6. Acute Syphilitic Posterior Placoid Chorioretinopathy (ASPPC): fundus photograph shows vast round placoid yellow zone in the posterior pole; the optic disk is hyperfluorescent in late FA angiograms. Fluorescein angiography reveals hyperfluorescence of the optic disk with a zone of hyperfluorescence in the posterior pole (tissue staining).
Structural OCT shows disruption of the ellipsoid zone and hyperreflective, nodular thickening of the RPE. Hyperreflective dots representing inflammatory cells are visible in the vitreous and attached to the posterior hyaloid.
- FA: retinal lesions have a typical pattern of early hypofluorescence followed by late staining. Commonly, optic nerve head shows a moderate hyperfluorescence staining in late phases without leakage (Figure 7);
- Blood tests: the traditional screening algorithm consists of non-treponemal tests (RPR or VDRL) used as initial screening, eventually confirmed by treponemal tests (FTA-ABS, TP-PA or EIA). Recently, the CDC introduced the reverse sequence algorithm that begins with new treponemal tests for IgM or IgG for T. pallidum (EIA/CIA) and is then confirmed by VDRL/ RPR; in case of disagreement, another treponemal test (FTA-ABS) is performed in order to confirm the disease. Regardless, in case of negativity, it is important to repeat blood tests because positivity becomes apparent 1-3 weeks after the infection.


7. FA in posterior uveitis secondary to syphilis: in both eyes, the optic nerve head shows a moderate hyperfluorescence staining in late phases without leakage. Fluorescein angiography of the patient’s right eye demonstrates the “leopard spot” pattern seen in acute syphilitic posterior placoid chorioretinitis.

- Cerebral spinal fluid analysis with VDRL, FTA-ABS, leucocytes count, and protein concentration is mandatory in patients with ocular involvement to exclude neurosyphilis and set the correct therapy.
- All affected patients should be screened for HIV infection.
When diagnosed, ocular syphilis is effectively treated with intravenous benzylpenicillin, and carries a favorable prognosis if adequately treated.
Treatment is usually set by an infectious disease specialist and depends on the stage of the disease:
- Primary and secondary syphilis are treated with single dose of intramuscular penicillin G 2,4 mln UI;
- Latent and tertiary syphilis (including ocular syphilis without neurosyphilis) are treated with intravenous penicillin G for 10-14 days.
In the case of ocular involvement, oral steroids are useful to control ocular inflammation, but it is important to start them after the beginning of antibiotics.
Retesting VDRL every 3 months is useful to monitor the efficacy of the therapy, since titers should become nonreactive in 1 year after therapy, otherwise the patient can be retreated.
Lyme disease (Borreliosis) is a vector-borne zoonosis caused by spirochaetes of the Borrelia burgdorferi complex transmitted by the bite of infected Ixodes ticks [43]. Ocular manifestations of Borreliosis are a rare feature of the disease, and they can vary by disease stage. In early Lyme disease, conjunctivitis (more often a nonspecific follicular conjunctivitis, in approximately 10% of patients) and photophobia can be observed. These are mild and transient, and ophthalmologists usually does not need to be consulted [44]. Significant ophthalmic complications may appear during stage 2 Lyme disease: blurred vision can be referred, and it is secondary to neuro-ophthalmic manifestations such as neuroretinitis, papilledema, optic atrophy, optic or retrobulbar neuritis, or pseudotumor cerebri. Retinitis is a rare presentation seen in the late disseminated stage (>3 months) of the disease. Ophthalmoscopic presentation is varied and nonspecific. Some authors described several features like engorged veins, hemorrhages, perivenous infiltrates, arterial occlusions, and retinal white spots (Figure 9). Signs of chronic uveitis with vitritis, cystoid macular edema, and retinal vasculitis were found too. Fluorescein angiography showed leakage from the veins, from the white spots, and from the optic disc [45]
Diagnosis is difficult because of the absence of gold standard, polymorphism of clinical symptoms, and frequency of false positive serology results. A tick bite is not necessary for diagnosis as it can go unnoticed in many cases. A positive ELISA and Immunoblot serology, the absence of a differential diagnosis (through exclusion of other causes), and the effectiveness of antibiotic therapy (decrease of inflammation) after a primary resistance to steroid treatment given alone are criteria to make the diagnosis of Lyme-associated uveitis. Treatment consists of oral doxycycline 200mg/day for 4 weeks, or ceftriaxone intravenously 1g/day for 3 weeks in association with local and oral (1mg/kg) steroids to reduce inflammation and functional sequelae. Despite posterior segment involvement and retinal vasculitis are rather frequent, prognosis is usually good, even though inflammation can be resistant or recurring [46]

Toxoplasmosis
Toxoplasmosis is a common zoonosis caused by the parasite Toxoplasma gondii and can occur in a congenital or acquired form [47]. Vertical transmission can happen when the woman acquires the first infection a few months before or during pregnancy and manifestations are more severe if maternal infection and subsequent transmission occur in the first months of pregnancy, even though transmission is more frequent in the last trimester with milder symptoms [48,49]
Toxoplasma gondii is an obligate intracellular parasite with a complex life cycle, and exists in three different forms: sporozoities are the result of its sexual cycle and are contained in oocysts released in the ambient by felines (the definitive hosts) through their feces. Once ingested by intermediate hosts (including humans), T. gondii undergoes two phases of asexual development: tachyzoites multiply rapidly in different host cells and later form tissue cysts with a special affinity for neuronal and muscle tissue; this is the terminal life-cycle stage in intermediate hosts where bradyzoites multiply slowly and remain dormant for many years, until cysts break, causing a reactivation of the disease. There are three main routes of infection: horizontally through oral ingestion of oocysts from the environment; horizontally by oral ingestion of tissue cysts contained in raw or undercooked meat (mainly lamb, pork, and chicken); vertically by transplacental transmission of tachyzoites or from mother to offspring through ingestion of milk harbouring tachyzoites [50]
T. gondii infection is asymptomatic in most cases in immunocompetent children and adults, but in 10% of cases, it causes a self-limiting non-specific illness with isolated cervical or occipital lymphadenopathy. Adults and children with ocular involvement usually complain of unilateral floaters and altered vision, with visual impairment and scotomas depending on the location of the lesions. Toxoplasmic chorioretinitis is the most common identifiable cause for posterior uveitis and focal retinitis. Necrotizing retinochoroiditis is the typical ocular manifestation, and ophthalmoscopically appears as fluffy white focal lesions with overlying vitreous inflammatory reaction, with the classic “headlight in the fog” appearance and adjacent pigmented old scar [51,52]. (Figures 10, 11). Anterior manifestations of active lesions can be present with various degrees of intensity and include inflammatory cells in the anterior chamber, granulomatous keratic precipitates, and rarely posterior synechiae. Inflammatory ocular hypertension can occur in 10% to 15% of cases. Untreated retinal lesions tend to heal after 1 to 2




11. Color fundus photograph of the right eye demonstrates an isolated active lesion along the superotemporal vascular arcade. FA shows early hypofluorescence of the active lesion, with associated focal retinal vasculitis.
months in immunocompetent subjects, leaving an hyperpigmented area with a chorioretinal atrophy centrally; recurrent lesions usually arise from the borders of older scars. OCT is an important tool to assess the stage of the disease (Figure 12): during the acute phase, posterior vitritis is demonstrated by multiple hyperreflective dots in the vitreous cavity, with posterior hyaloid thickening above areas of thickened and disrupted hyperreflective neurosensory retina, with photoreceptor interruption and RPE elevation. During follow-up, hyperreflective dots in the vitreous become smaller, posterior hyaloid usually detaches, and retinal layers become thinner but still disorganized, with RPE remaining elevated or becoming atrophic. Small oval hyperreflective deposits are described at the vitreoretinal interface during active phases; they


become smaller and enter in the inner retinal layers, progressively fading and disappearing during follow-up. Scars can appear at the OCT with various appearances: atrophic scars are sharply demarcated areas of retinal thinning and disorganization, with RPE atrophy and choroid thinning; deep scars are similar to the previous but have an excavated appearance; elevated scars show disorganization, elevation, and thickening of photoreceptors and RPE layer, with normal choroidal thickness [53] .
Ocular findings at clinical examination are almost always sufficient for diagnosis of ocular toxoplasmosis, without necessity for laboratory confirmation; IgG positivity demonstrates a past exposure to T. gondii, and its prevalence in industrialized countries is around 10-30%, so serological tests are solely used to exclude toxoplasmosis as the cause of the posterior uveitis [54]
In some cases, fundus examination is difficult due to dense vitritis, and PCR on vitreous samples can help draw definitive conclusions about the aetiology of the retinitis. Sensitivity for PCR detection is around 40%-60%, but this value can be improved by combining PCR and intraocular antibody testing, since the latter can be used to calculate Goldman-Witmer coefficient (a ratio between intraocular IgG and serological ones greater than 3 is considered diagnostic) [55,56] .
Treatment is a debated topic because no definitive medication exists, tissue cysts are resistant to any available drugs, and the disease usually resolves in 1 to 2 months in immunocompetent patients. The main goal of antitoxoplasmic drugs is reducing parasite multiplication during active retinitis; duration of disease and recurrences are usually similar between treated and untreated patients, but a greater reduction retinal lesions size was observed in treated patients. The classic triple therapy was pyrimethamine (25-50 mg once or twice daily), sulphadiazine (1 g four times daily) and corticosteroids, but trimethoprim-sulphametoxazole (TMP-SMX 160-800 twice daily) in association with prednisone demonstrated to be equally effective, to have fewer side effects, and a better compliance [57,58]. Before beginning therapy with TMP-SMX and 5-7 days later, a complete blood count, liver enzyme, and serum creatinine levels should be assessed to rule out pancytopenia; moreover, sulphonamide hypersensitivity may arise 7-14 days after initiating the therapy, but discontinuation of the therapy resolves both side effects.
Oral corticosteroids decrease inflammation and improve vision quality but should not be started without antitoxoplasmic drug.
During treatment, the rate of recurrences is definitely lower, but the prophylactic effect stops as the therapy is discontinued, so long-term use of antitoxoplasmic drugs should be considered in patients with frequent and severe recurrences or patients at great risk of vision loss due to lesions localization [59]
A suitable option for patients with recurrent infections is intravitreal injection of clyndamicine (1 mg) and prednisone (400 μg), which showed comparable clinical improvement and visual outcomes to oral therapy without systemic side effects [60]
Bartonellosis
Cat scratch disease (CSD) is an acquired infection caused by contact with cats infested with species of Gram-negative bacteria Bartonella, most commonly B. henselae. Infection can be followed by fever and regional lymphadenopathy, though general symptoms could be absent. In 5%-10% of patients with CSD, these eye conditions might develop: Parinaud’s oculoglandular syndrome, neuroretinitis, multi-focal retinitis, uveitis, retinal vessel occlusion, and retinal detachment [61,62]. Neuroretinitis is the most common posterior segment complication of CSD [63,64] and is typically characterized by optic disc edema and partial or complete “star-like” exudates around the macula, in association with mild vitritis. A reduction in the visual acuity can be referred [65]. The macular star often becomes manifest after the onset and may be present for up to 1 year. The macular star results from precipitation of lipidic exudates within the retinal Henle fibre layer, from leakage of the disc capillaries that had extended into the macular area along the plane of the outer plexiform layer, appearing progressively upon resorption of macular fluid [66]. Optic disc edema begins to decrease after 2 weeks with complete resolution occurring over the course of 2-3 months [67]
Culturing Bartonella spp. is challenging, requiring incubation times of between 2 and 6 weeks. For this reason, it is not widely performed; alternatively, serology or molecular detection using PCR are more commonly used.
There is no consensus on the CSD management or its ocular manifestations, but doxycycline 100 mg twice daily for 4-6 weeks is widely used in immunocompetent adults, while oral erythromycin can be used in children.
Tuberculosis
Tuberculosis (TB) is caused by Mycobacterium tuberculosis. TB affects the eye mainly via the bloodstream, and consequently the most vascular ocular tissue, the uvea, is most commonly affected. In fact, TB has traditionally been considered a disease of the uveal layers, especially the choroid. However, retinal involvement affects a large subgroup of patients presenting with ocular TB [68]. Tubercular uveitis (TBU) is typically a granulomatous inflammation. It may present as anterior, intermediate, posterior uveitis, panuveitis, or retinal vasculitis; posterior uveitis is the most common presentation [69]. Ocular TB (OTB) is a rare extrapulmonary form of the disease and represents a major diagnostic and therapeutic challenge, due to its heterogeneous clinical manifestations. The Collaborative Ocular Tuberculosis Study (COTS) evolved a survey-based consensus of uveitis experts to clear the profile of OTB: the clinically suggestive ocular features when supported by systemic presence of active or latent TB are sufficient to presumptively diagnose OTB and start anti-tubercular treatment (ATT) [70]. The reported prevalence of tubercular uveitis (TBU) is characterized by a wide variability worldwide, ranging from 0.2% to 2.7% in regions where TB is not endemic, including the U.S., Europe, and Japan, to 5.6%-10.5% in highly endemic areas, such as India [71]. Current evidence suggests a direct causative role of the bacilli in pathogenesis of retinal TB [72]
Clinical presentations of isolated retinal TB can include:
- retinal periphlebitis with or without focal chorioretinal lesions overlying blood vessels;
- Retinal periphlebitis in association with other forms of ocular TB, including coexisting multifocal serpigenoid choroiditis, neuroretinitis, or intermediate uveitis;
- Isolated retinitis lesions without periphlebitis, typically occurring as neuroretinitis;
- The previously called Eales’ disease: first described by Henry Eales in 1880, Eales’ disease was described as an idiopathic occlusive vasculitis involving the mid-peripheral retina and characterized by retinal venous inflammation (periphlebitis), vascular occlusion, and sub-



sequent retinal neovascularization with recurrent vitreous hemorrhage [73]. After, Eales’ disease has been associated with several causative factors, most prominently M. tuberculosis, and the term Eales’ disease is best avoided since it puts an unwarranted diagnostic label on a patient and possibly prevents clinicians from excluding potentially serious etiological conditions such as TB.
Tubercolar vascular retinitis (TVR) courses through the phases of inflammation, occlusion, neovascularization, and tractional complications. TRV courses through the phases of inflammation, occlusion, neovascularization, and tractional complications. The incidence of inflammatory vascular occlusion and the consequent peripheral capillary non-perfusion and extraretinal neovascularization varies by geography and ethnicity: it is more prevalent in Asian patients, rather than in white populations [74]. The COTS-1 study has further clarified that in the presence of specific patterns of choroiditis, serpiginous-like or a tuberculoma, OTB can be labeled merely with association of LTB (positive Tuberculin Skin test or Interferon-Gamma
Release Assay). For Tubercular Retinal Vasculitis, the diagnosis could be labeled tubercular only in the presence of latent TB AND radiological signs of healed TB in an endemic area [75,76]
The diagnosis of retinal TB is largely based on clinical and imaging characteristics.
FA: is fundamental for etiological diagnosis, as it reveals capillary non-perfusion in the sectors affected by retinal periphlebitis, typical of TVR. FA helps in identification of retinal and disc neovascularization. (Figure 13)
OCT: detects the presence of cystoid macular edema and other macular complications (macular hole, epiretinal membrane) and can also help distinguish a primarily retinal lesion from a choroidal one.
In TB-endemic regions, the presence of retinal periphlebitis associated with focal chorioretinal lesions overlying blood vessels and presence of capillary non-perfusion areas on FA/OCT angiography is highly suggestive of TB. The role of ancillary tests such as a tuberculin skin test, interferon-gamma release assay, and chest radiography provide useful supportive evidence, but neither their presence confirms the diagnosis nor their absence excludes ocular TB. A detailed clinical evaluation to exclude other etiology is more valuable in establishing the association with TB. In recent years, quantitative real-time PCR has been used to provide definitive evidence of M. tuberculosis in aqueous or vitreous samples from eyes with retinal TB.
FUNGI
Candida albicans
Candida albicans can infect the eye, penetrating by an external environment (e.g., surgical wound, trauma, corneal abscess) or can seed the chorioretinal tissues following a candidemia. It is strongly associated with intravenous drug abuse, but can be also found in patients with diabetes, malignancies, following major abdominal surgery, dialysis, urinary catheter, neutropenia, and immunosuppression [77] [60]
While Candida chorioretinitis with a peripheral seeding usually follows an indolent clinical course, the symptoms are scarce until the vitritis occurs. At this stage, a reduction of the visual acuity occurs following the vitreous opacification grade. On the other hand, if the infection occurs into the posterior pole, a rapid and irreversible loss of visual acuity occurs. For these reasons, a fundus retinal evaluation is recommended within the first week of therapy in non-neutropenic patients. For neutropenic patients, it’s best to delay the examination until neutrophil recovery [78] [61] .
Diagnosis [79] [62]
Positive blood cultures
Fundus examination
The classical chorioretinal lesion is creamy-white and well circumscribed, not exceeding 1 mm of diameter. It can be single or spread in multiple foci, and an overlying haze of vitreous inflammatory cells occurs frequently and vitreous opacities, connected by strands of inflammatory materials.
OCT features [80] [63]
Candida primary lesions are located into the inner choroid, but there can be difficulty seeing them by OCT examinations due to the inner chorioretinal and vitreous lesions’ shadowing. Features of these lesions have been described:
- Vitreous: a-specific signs as vitreous cellularity and posterior hyaloid thickening; peculiar sign named “rain-cloud sign”: round-shaped hyper-reflective preretinal aggregates with a homogeneous internal pattern packed between the retinal surface and the posterior hyaloid. An important shadowing of the rear tissues occurs.
– Retina: Intraretinal pattern: hyperreflective round-shaped lesion that does not exceed the inner nuclear layer and that can seed the preretinal space.
Chorioretinal pattern: thickening of the choriocapillary layer that appears hyporeflective, the RPE is disrupted, a little amount of subretinal fluid can be detected, and peculiar hyperreflective saw-tooth shaped exudates can be found.
Treatment [81] [64]
Because this chorioretinitis is part of a systemic infection, intravenous anti-mycotic therapy is needed and mandatory. Azoles are preferred, thanks to their better penetration through the blood-retinal barrier, if the mycotic agent is susceptible. If there is no vitritis, fluconazole, loading dose, 800 mg (12 mg/kg), then 400-800mg (6-12 mg/kg) daily should be prescribed; otherwise, voriconazole, loading dose 400mg (6 mg/kg) intravenous twice daily for 2 doses, then 300 mg (4 mg/kg) intravenous or oral twice daily, is recommended. The treatment should be continued for 4-6 weeks until the ophthalmoscopic resolution of the lesions. If a macular involvement is present, intravitreal injection of either amphotericin B deoxycholate 5–10 μg/0.1 mL, or voriconazole 100 μg/0.1 mL, is recommended to ensure a quick high level of antifungal activity.
With vitritis, the same therapy for macular involvement is also used; there is not unilateral consent to vitrectomy, as in the endophthalmitis vitrectomy study, they did not enroll patients with endogenous endophthalmitis. But studies have found vitrectomy as a good prognostic factor against further retinal detachment. If the microbial agent is unknown, vitrectomy could be useful to collect vitreous samples.
A clinical picture suggestive of TRV with detection of latent and healed TB is sufficient to start ATT. Since current evidence suggestive of M. tuberculosis is driven by inflammatory response, the treatment includes a combination of anti-TB therapy and systemic corticosteroids [82]. If the vasculitis is not severe and sight-threatening, ATT alone may be sufficient. In a sight-threatening case, systemic corticosteroid therapy should start and stop under ATT cover [83], supplemented by topical therapy for anterior uveitis. Anti-TB therapy is generally of 6 months’ duration with 2-month four-drug intensive phase and 4-month two-drug continuation phase [84]
Since retinal TB is commonly associated with peripheral ischemic areas and retinal and disk neovascularization, there is a significant role of intravitreal anti-VEGF agents. Surgical intervention could be required for management of sequele and complications [85]
Bibliography
1. Gupta N, Tripathy K. Retinitis. In Treasure Island (FL); 2021.
2. Urayama A, et al. Unilateral acute uveitis with retinal periarteritis and detachment. Jpn J Clin Ophthalmol. 1971; 25607-619.
3. Duker JS, Blumenkranz MS. Diagnosis and management of the acute retinal necrosis (ARN) syndrome. Surv Ophthalmol. 1991;35(5):327–43.
4. Sims JL, Yeoh J, Stawell RJ. Acute retinal necrosis: a case series with clinical features and treatment outcomes. Clin Experiment Ophthalmol. 2009;37(5):473–7.
5. Wensing B, de Groot-Mijnes JDF, Rothova A. Necrotizing and nonnecrotizing variants of herpetic uveitis with posterior segment involvement. Arch Ophthalmol (Chicago, Ill 1960). 2011 Apr;129(4):403–8.
6. Margolis R, Brasil OFM, Lowder CY, Smith SD, Moshfeghi DM, Sears JE, et al. Multifocal posterior necrotizing retinitis. Am J Ophthalmol. 2007;143(6):1003–8.
7. Lau CH, Missotten T, Salzmann J, Lightman SL. Acute retinal necrosis features, management, and outcomes. Ophthalmology. 2007;114(4):756–62.
8. Forster DJ, Dugel PU, Frangieh GT, Liggett PE, Rao NA. Rapidly progressive outer retinal necrosis in the acquired immunodeficiency syndrome. Am J Ophthalmol. 1990;110(4):341–8.
9. Engstrom REJ, Holland GN, Margolis TP, Muccioli C, Lindley JI, Belfort RJ, et al. The progressive outer retinal necrosis syndrome. A variant of necrotizing herpetic retinopathy in patients with AIDS. Ophthalmology. 1994;101(9):1488–502.
10. Carmichael A. Cytomegalovirus and the eye. Eye (Lond). 2012;26(2):237–40.
11. Port AD, Orlin A, Kiss S, Patel S, D’Amico DJ, Gupta MP. Cytomegalovirus Retinitis: A Review. J Ocul Pharmacol Ther. 2017;33(4):224–34.
12. D’Amico DJ, Talamo JH, Felsenstein D, Hirsch MS, Albert DM, Schooley RT. Ophthalmoscopic and histologic findings in cytomegalovirus retinitis treated with BW-B759U. Arch Ophthalmol (Chicago, Ill 1960). 1986;104(12):1788–93.
13. Vannozzi L, Bacherini D, Sodi A, Beccastrini E, Emmi G, Giorni A, Menchini U. Cytomegalovirus retinitis following intravitreal dexamethasone implant in a patient with central retinal vein occlusion. Acta Ophthalmol. 2016;94(2):e158-60. doi: 10.1111/ aos.12783. Epub 2015 Jul 14. PMID: 26172582.
14. Young NJ, Bird AC. Bilateral acute retinal necrosis. Br J Ophthalmol. 1978;62(9):581–90.
15. Ohtake-Matsumoto A, Keino H, Koto T, Okada AA. Spectral domain and swept source optical coherence tomography findings in acute retinal necrosis. Vol. 253, Graefe’s archive for clinical and experimental ophthalmology. Albrecht von Graefes Archiv fur klinische und experimentelle Ophthalmologie. Germany; 2015. p. 2049–51.
16. Kurup SP, Khan S, Gill MK. Spectral domain optical coherence tomography in the evaluation and management of infectious retinitis. Retina. 2014;34(11):2233–41.
17. Ward TS, Reddy AK. Fundus autofluorescence in the diagnosis and monitoring of acute retinal necrosis. J Ophthalmic Inflamm Infect. 2015;5:19.
18. Yeh S, Wong WT, Weichel ED, Lew JC, Chew EY, Nussenblatt RB. Fundus Autofluorescence and OCT in the Management of Progressive Outer Retinal Necrosis. Ophthalmic surgery, lasers imaging. Off J Int Soc Imaging Eye. 2010;1–4.
19. Tam PMK, Hooper CY, Lightman S. Antiviral selection in the management of acute retinal necrosis. Clin Ophthalmol. 2010;4:11–20.
20. Aizman A, Johnson MW, Elner SG. Treatment of acute retinal necrosis syndrome with oral antiviral medications. Ophthalmology. 2007;114(2):307–12.
21. Huynh TH, Johnson MW, Comer GM, Fish DN. Vitreous penetration of orally administered valacyclovir. Am J Ophthalmol. 2008;145(4):682–6.
22. Flaxel CJ, Yeh S, Lauer AK. Combination systemic and intravitreal antiviral therapy in the management of acute retinal necrosis syndrome (an American Ophthalmological Society thesis). Trans Am Ophthalmol Soc. 2013;111:133–44.
23. Schoenberger SD, Kim SJ, Thorne JE, Mruthyunjaya P, Yeh S, Bakri SJ, et al. Diagnosis and Treatment of Acute Retinal Necrosis: A Report by the American Academy of Ophthalmology. Ophthalmology. 2017;124(3):382–92.
24. Biron KK. Antiviral drugs for cytomegalovirus diseases. Antiviral Res. 2006;71(2–3):154–63.
25. Beck AP, Jampol LM, Glasser DA, Pollack JS. Is Coxsackievirus the Cause of Unilateral Acute Idiopathic Maculopathy? Arch Ophthalmol. 2004;122(1):121–123. doi:10.1001/archopht.122.1.121.
26. Freund KBYannuzzi LABarile GSpaide RFMilewski SAGuyer DR The expanding clinical spectrum of unilateral acute idiopathic maculopathy. Arch Ophthalmol. 1996;114555-559.
27. Varga Z., Flammer A.J., Steiger P. et al. Endothelial cell infection and endotheliitis in COVID-19. Lancet. 2020; 395: 1417-1418.
28. Casagrande M., Fitzek A., Püschel K. et al. Detection of SARS-CoV-2 in human retinal biopsies of deceased COVID-19 patients. Ocul Immunol Inflamm. 2020; 1-5.
29. Invernizzi A, Torre A, Parrulli S, Zicarelli F, Schiuma M, Colombo V, Giacomelli A, Cigada M, Milazzo L, Ridolfo A, Faggion I, Cordier L, Oldani M, Marini S, Villa P, Rizzardini G, Galli M, Antinori S, Staurenghi G, Meroni L. Retinal findings in patients with COVID-19: Results from the SERPICO-19 study. EClinicalMedicine. 2020;27:100550. doi: 10.1016/j.eclinm.2020.100550. Epub 2020 Sep 20. PMID: 32984785; PMCID: PMC7502280.
30. Caporossi T, Bacherini D, Tartaro R, VIrgili G, Peris A, Giansanti F. Retinal findings in patients affected by COVID 19 intubated in an intensive care unit. Acta Ophthalmol. 2021;99(7):e1244-e1245. doi: 10.1111/aos.14734. Epub 2020 Dec 30. PMID: 33377599.
31. Jameson JL, Kasper DL, Longo DL, Fauci AS, Hauser SL, Loscalzo J. Harrison’s principles of internal medicine. 2018.
32. Aldave AJ, King JA, Cunningham ETJ. Ocular syphilis. Curr Opin Ophthalmol. 2001;12(6):433–41.
33. O’Byrne P, Macpherson P. Syphilis. BMJ. 2019;365(June):1–11.
34. Li SY, Birnbaum AD, Tessler HH, Goldstein DA. Posterior syphilitic uveitis: Clinical characteristics, co-infection with HIV, response to treatment. Jpn J Ophthalmol. 2011;55(5):486–94.
35. Reddy S, Cubillan LDP, Hovakimyan A, Cunningham ET. Inflammatory ocular hypertension syndrome (IOHS) in patients with syphilitic uveitis. Br J Ophthalmol. 2007;91(12):1610–2.
36. Schwartz LK, O’Connor GR. Secondary syphilis with iris papules. Am J Ophthalmol [Internet]. 1980;90(3):380–4.
37. Pichi F, Neri P. Multimodal imaging patterns of posterior syphilitic uveitis: a review of the literature, laboratory evaluation and treatment. Int Ophthalmol [Internet]. 2020;40(5):1319–29.
38. Fu EX, Geraets RL, Dodds EM, Echandi L V., Colombero D, McDonald HR, et al. Superficial retinal precipitates in patients with syphilitic retinitis. Retina. 2010;30(7):1135–43.
39. Gass JDM, Braunstein RA, Chenoweth RG. Acute Syphilitic Posterior Placoid Chorioretinitis. Ophthalmology [Internet]. 1990;97(10):1288–97.
40. Pichi F, Ciardella AP, Cunningham ETJ, Morara M, Veronese C, Jumper JM, et al. Spectral domain optical coherence tomography findings in patients with acute syphilitic posterior placoid chorioretinopathy. Retina. 2014;34(2):373–84.
41. Singh AE. Ocular and neurosyphilis: Epidemiology and approach to management. Curr Opin Infect Dis. 2020;33(1):66–72.
42. Koundanya V V., Tripathy K. Syphilis Ocular Manifestations. StatPearls [Internet]. 2020;1–8.
43. Stanek G, Wormser GP, Gray J, Strle F. Lyme borreliosis. Lancet [Internet]. 2012;379(9814):461–73.
44. Lesser RL. Ocular manifestations of Lyme disease. Am J Med. 1995;98(4A):60S-62S.
45. Leys AM, Schönherr U, Lang GE, Naumann GO, Goubau P, Honore A, et al. Retinal vasculitis in Lyme borreliosis. Bull Soc Belge Ophtalmol. 1995;259:205–14.
46. Bernard A, Seve P, Abukhashabh A, Roure-Sobas C, Boibieux A, Denis P, et al. Lyme-associated uveitis: Clinical spectrum and review of literature. Eur J Ophthalmol. 2020 Sep;30(5):874–85.
47. Pleyer U, Schlüter D, Mänz M. Ocular toxoplasmosis: Recent aspects of pathophysiology and clinical implications. Ophthalmic Res. 2014;52(3):116–23.
48. Garza-Leon M, Arellanes Garcia L. Ocular toxoplasmosis: Clinical characteristics in pediatric patients. Ocul Immunol Inflamm. 2012;20(2):130–8.
49. Montoya JG, Liesenfeld O. Toxoplasmosis. 2004;363:1965–76.
50. Tenter AM, Heckeroth AR, Weiss LM. Toxoplasma gondii: From animals to humans. Int J Parasitol. 2000;30(12–13):1217–58.
51. Butler NJ, Furtado JM, Winthrop KL, Smith JR. management. 2014;41(1):95–108.
52. Rothova A. Ocular manifestations of toxoplasmosis. Curr Opin Ophthalmol. 2003;14(6):384–8.
53. Goldenberg D, Goldstein M, Loewenstein A, Habot-Wilner Z. Vitreal, retinal, and choroidal findings in active and scarred toxoplasmosis lesions: A prospective study by spectral-domain optical coherence tomography. Graefe’s Arch Clin Exp Ophthalmol. 2013;251(8):2037–45.
54. Ozgonul C, Besirli CG. Recent Developments in the Diagnosis and Treatment of Ocular Toxoplasmosis. Ophthalmic Res. 2017;57(1):1–12.
55. Van Gelder RN. CME review: Polymerase chain reaction diagnostics for posterior segment disease. Retina. 2003;23(4):445–52.
56. Montoya JG, Parmley S, Liesenfeld O, Jaffe GJ, Remington JS. Use of the polymerase chain reaction for diagnosis of ocular toxoplasmosis. Ophthalmology. 1999;106(8):1554–63.
57. Soheilian M, Sadoughi MM, Ghajarnia M, Dehghan MH, Yazdani S, Behboudi H, et al. Prospective randomized trial of trimethoprim/sulfamethoxazole versus pyrimethamine and sulfadiazine in the treatment of ocular toxoplasmosis. Ophthalmology. 2005;112(11):1876–82.
58. Zhang Y, Lin X, Lu F. Current treatment of ocular toxoplasmosis in immunocompetent patients: A network meta-analysis. Acta Trop [Internet]. 2018;185:52–62.
59. Silveira C, Muccioli C, Nussenblatt R, Belfort R. The effect of long-term intermittent trimethoprim/sulfamethoxazole treatment on recurrences of toxoplasmic retinochoroiditis: 10 years of follow-up. Ocul Immunol Inflamm. 2015;23(3):246–7.
60. Soheilian M, Ramezani A, Azimzadeh A, Sadoughi MM, Dehghan MH, Shahghadami R, et al. Randomized trial of intravitreal clindamycin and dexamethasone versus pyrimethamine, sulfadiazine, and prednisolone in treatment of ocular toxoplasmosis. Ophthalmology [Internet]. 2011;118(1):134–41.
61. Chu BCY, Tam VTY. A serologically proven case of cat-scratch disease presenting with neuroretinitis. Hong Kong Med J = Xianggang yi xue za zhi. 2009;15(5):391–3.
62. Cunningham ET, Koehler JE. Ocular bartonellosis. Am J Ophthalmol. 2000;130(3):340–9.
63. Habot-Wilner Z, Trivizki O, Goldstein M, Kesler A, Shulman S, Horowitz J, et al. Cat-scratch disease: ocular manifestations and treatment outcome. Acta Ophthalmol. 2018;96(4):e524–32.
64. Chi SL, Stinnett S, Eggenberger E, Foroozan R, Golnik K, Lee MS, et al. Clinical characteristics in 53 patients with cat scratch optic neuropathy. Ophthalmology. 2012;119(1):183–7.
65. Johnson A. Ocular complications of cat scratch disease. Br J Ophthalmol. 2020;104(12):1640–6.
66. Finger, M., Borruat, FX. Dynamics of intraretinal fluid accumulation evidenced by SD-OCT in a case of cat scratch neuroretinitis. Eye 28, 770–771 (2014).
67. Ksiaa I, Abroug N, Mahmoud A, Zina S, Hedayatfar A, Attia S, et al. Update on Bartonella neuroretinitis. J Curr Ophthalmol. 2019;31(3):254–61.
68. Basu, S., & Das, T. (2017). Tubercular Retinitis and Retinal Vasculitis. Ocular Tuberculosis, 89–94. doi:10.1007/978-3-319-57520-9_9.
69. Shukla D, Kalliath J, Dhawan A. Tubercular Retinal Vasculitis: Diagnostic Dilemma and Management Strategies. Clin Ophthalmol. 2021;15:4681-4688. Published 2021 Dec 15. doi:10.2147/OPTH.S284613.
70. Agrawal R, Gunasekeran DV, Grant R, et al. Clinical features and outcomes of patients with Tubercular Uveitis treated with antitubercular therapy in the Collaborative Ocular Tuberculosis Study (COTS)-1 [published correction appears in JAMA Ophthalmol. 2019 Feb 1;137(2):233]. JAMA Ophthalmol. 2017;135(12):1318–1327. doi:10.1001/jamaophthalmol.2017.4485.
71. Ang M, Chee SP. Controversies in ocular tuberculosis. Br J Ophthalmol. 2017;101(1):6-9. doi: 10.1136/bjophthalmol-2016-309531. Epub 2016 Nov 4. PMID: 27815270.
72. Basu, S., & Das, T. (2017). Tubercular Retinitis and Retinal Vasculitis. Ocular Tuberculosis, 89–94. doi:10.1007/978-3-319-575209_9
73. Eales H. Cases of retinal haemorrhage, associated with epistaxis and constipation. Birmingham: Hall and English; 1880.
74. Gunasekeran DV, Agrawal R, Agarwal A, et al. The Collaborative Ocular Tuberculosis Study (COTS)-1: a multinational review of 251 patients with tubercular retinal vasculitis. Retina. 2019;39(8):1623–1630. doi:10.1097/IAE.0000000000002194.
75. Agrawal R, Testi I, Bodaghi B, et al. Collaborative ocular tuberculosis study consensus guidelines on the management of Tubercular Uveitis-Report 2: guidelines for Initiating antitubercular therapy in anterior uveitis, intermediate uveitis, panuveitis, and retinal vasculitis. Ophthalmology. 2021;128(2):277–287. doi:10.1016/j.ophtha.2020.06.052.
76. Gunasekeran DV, Agrawal R, Agarwal A, et al. The Collaborative Ocular Tuberculosis Study (COTS)-1: a multinational review of 251 patients with tubercular retinal vasculitis. Retina. 2019;39(8):1623–1630. doi:10.1097/IAE.0000000000002194.
77. Nagao M, Saito T, Doi S, Hotta G, Yamamoto M, Matsumura Y, et al. Clinical characteristics and risk factors of ocular candidiasis. Diagn Microbiol Infect Dis. 2012;73(2):149–52.
78. Sallam A, Taylor SRJ, Khan A, McCluskey P, Lynn WA, Manku K, et al. Factors determining visual outcome in endogenous Candida endophthalmitis. Retina. 2012 Jun;32(6):1129–34.
79. Oude Lashof AML, Rothova A, Sobel JD, Ruhnke M, Pappas PG, Viscoli C, et al. Ocular manifestations of candidemia. Clin Infect Dis an Off Publ Infect Dis Soc Am. 2011;53(3):262–8.
80. Invernizzi A, Symes R, Miserocchi E, Cozzi M, Cereda M, Fogliato G, et al. SPECTRAL DOMAIN OPTICAL COHERENCE TOMOGRAPHY FINDINGS IN ENDOGENOUS CANDIDA ENDOPHTHALMITIS AND THEIR CLINICAL RELEVANCE. Retina. 2018 May;38(5):1011–8.
81. Pappas PG, Kauffman CA, Andes DR, Clancy CJ, Marr KA, Ostrosky-Zeichner L, et al. Executive Summary: Clinical Practice Guideline for the Management of Candidiasis: 2016 Update by the Infectious Diseases Society of America. Clin Infect Dis an Off Publ Infect Dis Soc Am. 2016;62(4):409–17.
82. Bansal R, Gupta A, Gupta V, Dogra MR, Bambery P, Arora SK. Role of anti-tubercular therapy in uveitis with latent/manifest tuberculosis. Am J Ophthalmol. 2008;146(5):772–9.
83. Agrawal R, Gunasekeran DV, Grant R, et al. Clinical features and outcomes of patients with Tubercular Uveitis treated with antitubercular therapy in the Collaborative Ocular Tuberculosis Study (COTS)-1 [published correction appears in JAMA Ophthalmol. 2019 Feb 1;137(2):233]. JAMA Ophthalmol. 2017;135(12):1318–1327. doi:10.1001/jamaophthalmol.2017.4485.
84. Kelgaonkar A, Govindhari V, Khalsa A, Basu S. Anti-tubercular therapy alone for treatment of isolated tubercular retinal vasculitis [published online ahead of print, 2021 Aug 9]. Eye. 2021. doi:10.1038/s41433-021-01727-3
85. Bansal R, Dogra M, Chawla R, Kumar A. Pars plana vitrectomy in uveitis in the era of microincision vitreous surgery. Indian J Ophthalmol. 2020;68(9):1844–1851. doi:10.4103/ijo.IJO_1625_20.
Massimo Nicolò, Carlo Catti
Retinopathy of prematurity (ROP) is one of the most important causes of preventable visual impairment and blindness in pediatric age. ROP is a condition characterized by aberrant neovascularization, fibrovascular proliferation, and the potential resulting retinal detachment, which can severely impair visual function. Other possible sequelae are glaucoma, strabismus, myopia, and amblyopia.
Initially known as “retrolental fibroplasia,” it was first identified in Boston in 1942 by Theodor Lasater Terry on a premature infant, hence the term “Terry’s disease”1
Since 1984, the International Classification of ROP (ICROP) group has developed a classification system for the disease, which has been updated over several editions, with the most recent being the third version in 2021. The ROP classification system divides findings based on the zone of onset, the stage, and the presence or absence of “plus” or “pre-plus” disease2 . There are three development zones, five levels of severity, and the presence or absence of “plus disease.” The “Aggressive ROP” subtype (A-ROP) is characterized by rapid abnormal neovascularization and the onset of plus disease, with progression that does not necessarily follow the usual stages of ROP progression in the most posterior part of the retina.
The first historical randomized clinical trial for the treatment of ROP was the Cryotherapy for Retinopathy of Prematurity Cooperative Group (CRYO-ROP), published in 1990 and updated in 20053, which involved treating ROP with cryotherapy, albeit with high complication rates. Currently, the management and treatment of ROP are primarily guided by the results of the Early Treatment of Retinopathy of Prematurity Randomized Trial (ETROP) 4 of 2003, which promotes early diagnosis and treatment.
The development of retinal vascularization begins around the 12th week of gestation, starting from the optic nerve and expanding from the center of the posterior pole towards the periphery, mainly under the influence of VEGF (Vascular Endothelial Growth Factor). The complete development of peripheral retinal vascularization continues and concludes in the postnatal period. Premature birth critically disrupts the proper development of retinal vascularization, thereby promoting the development of aberrant neovascularization.
The main etiological hypothesis of ROP involves a two-phase mechanism: in the first phase, immediately after birth and up to the 32nd week of postmenstrual age, there is a slowed progression of normal postnatal retinal vascularization, accompanied by vasoconstriction and sometimes occlusion. This is mainly due to a series of factors such as hyperoxia (even ambient oxygen induces hyperoxia in premature infants because it is higher compared to the intrauterine environment), low levels of insulin-like growth factor 1 (IGF-1), and delayed expression of the VEGF receptor 2. In the second phase, identified between the fourth and
eighth week of postnatal life, there is abnormal proliferation of vascular cells, with neovascularization of the retina and vitreous body stimulated by VEGF produced by the avascular peripheral retina. The hypoxia of the peripheral retina is the most important stimulus for the production of neovascular agents because it activates the transcription of proangiogenic genes such as erythropoietin, angiopoietin 2, and VEGF by hypoxic cells.5;6
Among the numerous factors identified in the development of ROP, the main ones are low gestational age, low birth weight, and exposure to high oxygen levels at birth and in the postnatal period7. Regarding the latter, there are directly proportional correlations between the levels of administered oxygen and the risk of developing ROP. Intermittent hypoxia (SpO2 <80% for one minute or more) and fluctuations in ambient oxygen levels during the neonatal period are also correlated with the risk of ROP onset. These considerations have led to the understanding that the administration of appropriate oxygen levels in neonatal intensive care units during the critical postpartum period is one of the cornerstones of ROP prevention. Resuscitation procedures with 100% oxygen saturation can significantly expose newborns to the development of ROP. However, it is a delicate balance to maintain, as meta-analysis studies have shown that newborns treated with low oxygen saturation levels (85-89%) had a reduced risk of developing severe ROP compared to the group treated with higher saturations (91-95%), but with an increased risk of death between 18 and 24 months (RR 1.16)8. A systematic literature review9 found that most studies and reports from the American Academy of Pediatrics suggest maintaining a saturation level between 90% and 95% in neonatal intensive care units because lower saturation levels seem to be associated with an increased rate of neonatal mortality, but not to a statistically significant correlation with the development of potential disabilities. For ethical reasons, there are no randomized clinical trials comparing outcomes at lower saturation levels. Retrospective studies, though present, are often subject to bias, making the current standard of care maintain a saturation level between 90 and 95%10 Prenatal administration of corticosteroids appears to reduce the risk of severe ROP. Prospective studies show that administering corticosteroids to mothers at risk of preterm birth between the 23rd and 30th weeks reduces the incidence of severe ROP in newborns by promoting lung maturation and respiratory independence11. Currently, new American studies show that pain management, infection prevention, nutrition, temperature control, and life support in the postnatal period are all involved in controlling the onset of ROP. Among the new factors being investigated in the onset of ROP, hyperglycemia (gestational diabetes) and the role of breastfeeding are currently under study.12,13
In 2010, an estimated 184,700 (169,600 – 214,500) cases of ROP were reported among premature infants, with about 20,000 developing severe visual function impairment and about 12,000 developing mild to moderate impairment. Two-thirds of the cases were found in developing countries, correlating with the infant mortality rate in the countries examined.14,15 Historically, three epidemics of ROP have been identified in recent history. The first epidemic occurred in the 1940s in Western industrialized countries, coinciding with the introduction of neonatal intensive care. The pioneering postnatal support techniques at the time were not standardized and involved liberal oxygen administration, leading to the initial identification and investigation of ROP. The second epidemic peak occurred in the 1960s with the improvement of neonatal intensive care and increased survival rates of infants with birth weights too low for previous forms of treatment. In the 1990s, the exportation of neonatal intensive
care to developing countries led to an increase in the survival of premature and underweight infants in the poorer regions of the world. However, the often emerging and extremely necessary conditions in which these care units operated have led to a resurgence of ROP, increasing its frequency.16,17
Currently, sub-Saharan Africa is the area with the highest incidence of ROP. Since the early 1990s, significant efforts have been made to improve neonatal care standards in sub-Saharan countries, reducing neonatal mortality by at least 40%. Currently, 28% of the world’s premature infants are born in these countries. This, combined with the improvement of basic postnatal care and average survival rates, means that many of these preterm infants are at risk of developing ROP, even in severe forms. A major contributing factor to this increased incidence seems to be the lack of proper oxygen-mixing equipment in many nurseries in sub-Saharan countries. This technical shortfall means that infants are exposed to irregular oxygenation regimes, not based on the newborn’s saturation, thus increasing the risk of ROP.10 In industrialized countries, data on the incidence among at-risk populations (infants weighing less than 1500 grams and/or postmenstrual age below 32 weeks) vary. A British study showed that in 2011, the incidence of premature infants with signs of ROP (though not necessarily progressing or requiring treatment) was 12.6%.18 In the USA, the incidence was 16.4%.19 Taiwan reported an incidence of 36.6% between 2002 and 2011.20 In South Korea, two different studies reported an incidence ranging from 29.8% to 31.7%,21,22 while China reported an incidence of 15.9%.23
Classification
ROP is staged according to the parameters of the International Classification of Retinopathy of Prematurity (ICROP), which reached its third revision in 2021.2 ROP is localized in three possible concentric zones starting from the optic disc. Zone I is centered on the optic nerve head with a radius defined as twice the distance between the macula and the optic nerve (roughly two disc diameters). Zone II extends from the edge of Zone I to the nasal ora serrata. The new ICROP-3 classification further divides it into posterior Zone II (extending from the edge of Zone I for a space of two disc diameters) and peripheral Zone II to better stratify ROP cases

a demarcation line, Stage I lesion in
Type 1 ROP
Type 2 ROP
- Zone I, any stage with plus disease
- Zone I, stage 3 without plus disease
- Zone II, stage 2 or 3 with plus disease
- Zone I, stage 1 or 2 without plus disease
- Zone II, stage 3 without plus disease
Table 1. ETROP classification and clinical management algorithm4
Treatment
Observation
within Zone II. Zone III extends from the edge of peripheral Zone II and includes the remaining retina up to the temporal ora serrata, with a crescent shaped morphology. (Figure 1)
A new term, “notch,” describes an extension of the neovascular lesion of up to two clock hours along the horizontal meridians from a more peripheral zone to a more posterior zone. In the case of a notch, the classification zone should be the most posterior zone involved; thus, a Zone II lesion with a notch in Zone I should be defined as “Zone I secondary to notch.”
ROP is also classified into type I or type II ROP (Table 1) according to the parameters defined by the ETROP study, which recommends intervention in more severe cases, defined as type I ROP, or close observation in milder cases, classified as type II ROP. This classification system helps determine the severity of the disease and guide appropriate management and intervention strategies.
“Plus disease” is a finding in ROP characterized by vascular tortuosity and dilatation of the vessels. The term was first introduced in the initial ICROP classification of 1984. The term “preplus disease” (Figure 2)2 was introduced in the second classification of 2005 to describe a state of abnormal vascular tortuosity and congestion that does not meet the criteria for “plus disease” (Figures 3 and 4).2
The first definition of plus disease included several findings that are now considered signs of severe disease but are not sufficient to define plus disease, such as iris vessel congestion and vitreous haze. The ICROP committee recommends the definition of plus or preplus disease be based on the examination of vessels in Zone I, taking into account that morphological alterations of vascularization develop on a continuous spectrum of changes and that the definition is not always consistent among different examiners.24;25



3.
significant arteriovenous dilation and vascular tortuosity. White arrows indicate a peripheral portion that is difficult to evaluate from the fundus photo, suggestive of stage 3 neovascularization but with a flattened morphology.
There are five main stages in the ROP classification. In the absence of retinal vascularization, the ICROP committee suggests using the term “Incomplete Vascularization”, followed by the described zone. When neovascularization appears at the border between the avascular zone and the vascularized zone, a staging system is used to define its progression. In case of concurrent stages, classification is based on the most severe stage2
1) Demarcation Line: A thin line at the junction between the vascularized and avascular portions of the retina. It appears flat and pale. Vascular tortuosity and dilation without a demarcation line are insufficient for a diagnosis of stage 1 disease. (Figure 5)2
2) Ridge: A ridge of variable width and height that originates from the demarcation line. The color can vary from white to pink. (Figure 6)2 Sometimes, clusters of neovascular tissue, known as “popcorn”, may be seen on the retinal surface posterior to the ridge.



7. Stage 3, neovascularization at the ridge (white tips), ridge without neovessels (black tips), and peripheral “popcorn” (white arrows).

Figure 8. Aggressive ROP with severe vasoconstriction and hypoperfusion, tortuous vessels, arteriovenous shunting, hemorrhage, and plus disease in Zone I.
3) Extraretinal Fibrovascular Neovascularization: A process of neovascularization involving the vitreous, starting from the ridge, giving the ridge’s edge a serrated appearance. Stage 3 is sometimes difficult to identify in Zone I or posterior Zone II, as the ridge is often less prominent. (Figure 7)2
The term was introduced in the 2005 classification to describe a rapidly progressive form of ROP occurring in posterior Zone II or Zone I. Previously known as “rush disease”26, it particularly spread in the 1940s, during the first epidemic of ROP. This form of the disease is characterized by aggressive and rapidly progressive neovascularization that doesn’t follow the normal stages of ROP development and can occur in any zone (Figure 8)2. It mainly affects high-risk premature infants due to low postmenstrual age at birth, low birth weight, and oxygen exposure. Its rapidly progressive presentation with atypical features not related to the usual stages of ROP progression often makes timely identification challenging. Occasionally, congested and tortuous vessels with anomalous arteriovenous shunts can be identified at the border of the vascularized portion of the retina. Other forms of early but insidious presentation include the onset of thin and difficult-to-identify new vessels in Zone I or stage 3 neovascularization in the vitreous with a flattened appearance2
Detachment (Stages 4 – 5)
4) Partial Retinal Detachment: this can be further divided into partial retinal detachment without macular involvement (4A) (Figure 9)2 or with macular involvement (4B) (Figure 10)2. The detachment can be exudative or tractional. Exudative forms may follow laser treatment, often with a convex appearing retina and self-limiting detachment. In tractional detachment, there is progressive fibrovascular organization and vitreous opacity. A characteristic “volcano-shaped” detachment may occur in aggressive ROP, where the peripheral retina remains attached, and the detachment develops centrally.2,27
5) Total Retinal Detachment (Figure 11)2: Subclassified based on the funnel shape: “openopen” if open both anteriorly and posteriorly, “open-closed” if open anteriorly and closed posteriorly, or “closed-closed” if closed both anteriorly and posteriorly. The ICROP committee suggests dividing the Stage 5 into three sub-stages: 5A, where the optic disc can



be observed with the ophthalmoscope, 5B, where the optic disc cannot be visualized due to neovascularization or closed funnel detachment, and 5C, where stage 5B features are accompanied by anterior segment abnormalities (anterior displacement of the lens, shallowing of the anterior chamber, iridolenticular synechiae, corneal opacities)2
Screening programs for ROP are based on evidence-based criteria for the accurate identification of infants at risk for the disease and complications that could impair proper visual function development. The support from neonatologists is crucial for the early identification of infants with low birth weight or those born prematurely. Guidelines vary slightly between countries, but they are primarily based on birth weight and gestational age parameters. Currently, in Italy, screening guidelines include birth before 30 weeks postmenstrual age or birth weight below 1500g. Infants with a birth weight between 1500 and 2000g who are born after 30 weeks of gestation, with complicated delivery or postpartum clinical course and requiring ventilatory support are also included28.

Numerous efforts have been made to refine the application of ROP screening worldwide. In 2006, Lofqvist et al. published and subsequently refined the WINROP (Weight, insulin-like growth factor-1 (IGF-1), Neonatal, Retinopathy of Prematurity model)29 screening algorithm, which is based on monitoring postnatal weight and serum IGF-1 levels to assess the risk of developing ROP. Other proposed screening optimization algorithms include the Children’s Hospital of Philadelphia (CHOP)30 model and the Postnatal growth and retinopathy of prematurity (G-ROP) model31
Diagnosis is based on ophthalmoscopic examination with a 28D or 20D lens and fundus photography, with periodic follow-up based on disease severity and performed treatment. Table 2 shows the follow-up interval recommendations according to the joint consensus of the American Academy of Ophthalmology and the American Academy of Pediatrics.32
Instrumental diagnostics primarily rely on OCT and retinal fluorescein angiography. Vascular imaging in other forms, such as color Doppler of the central retinal artery and ophthalmic artery, has not shown significant utility in diagnosing the disease, but 2016 studies demonstrated increased systolic flow velocity one month after anti-VEGF administration in Doppler ultrasound33. Retinal fluorescein angiography is useful both in staging the disease (Figure 12)2 , showing greater sensitivity compared to ophthalmoscopic examination,34,35 and in evaluating therapy outcomes, as well as guiding laser treatment and any additional anti-VEGF treatments.36,37 Variations such as delayed choroidal filling, arteriovenous shunts, macular vessel
American Academy of Pediatrics Recommendations for ROP Eye Examination Follow-up Intervals
Interval
1 week or less
1 to 2 weeks
2 weeks
2 to 3 weeks
Recommendation
Immature vascularization: zone I or posterior zone II
Stage 1 or 2 ROP: zone I
Stage 3 ROP: zone II
Presence or suspected presence of aggressive posterior ROP
Immature vascularization: posterior zone II
Stage 2 ROP: zone II
Unequivocally regressing ROP: zone I
Stage 1 ROP: zone II
Immature vascularization: zone II
Unequivocally regression ROP: zone II
Stage 1 or 2 ROP: zone III
Regressing ROP: zone III
hypoplasia, capillary hypoperfusion, and rosary-bead-like hyperfluorescence have been described. There also appears to be a correlation between low gestational age (<30 weeks) and low birth weight (<1100g) with the development of a reduced or even absent foveal avascular zone (FAZ). Efforts are currently underway to implement AI in ROP diagnosis, with promising results38
Regarding OCT and OCT-A, these are often underused in the diagnosis and staging of ROP due to the difficulty in subjecting infants to these exams and the limited availability of validated pediatric devices, making themmore easily applicable to older and cooperative children for follow-up evaluation. Typical OCT findings in the inactive phase of the disease include the presence of a reduced FAZ with macular hypoplasia/aplasia and often a corresponding degree of amblyopia (Figure 13)2. Current studies are focusing on identifying a possible increase in vascular density in the foveal region of the superficial and deep capillary plexuses compared to healthy age-matched controls, with conflicting results39-42

The initial ROP treatment models involved the use of surgical and para-surgical techniques such as cryotherapy for ablating the avascular portion of the retina.3 With the introduction of laser photocoagulation in the 1990s, cryoablation fell out of favor. Laser photocoagulation is still considered by many as the gold standard of care, with a regression of the pathology in 90% of cases43,44 (Figure 14)2. Laser treatment is performed after either local, general anesthesia, or deep sedation, depending on the proposed protocols. The laser is applied to the avascular peripheral retina using indirect ophthalmoscopy. Some authors suggest performing treatment even posterior to the demarcation line or ridge.45
The destruction of the avascular retina by laser photocoagulation reduces the progression of aberrant neovascularization. However, complications such as axial myopia, cataract, anterior segment ischemia, glaucoma, and retinal detachment may arise following treatment. In particular, there seems to be a correlation between the number of laser spots applied and the proportional development of myopia.7,46
Pharmacological therapy allows for blocking disease progression and maintaining visual function, promoting normal postnatal vascular development. Over the past 15 years, the effectiveness and optimal use of intravitreal anti-VEGF agents have been extensively explored and documented.
Four different anti-VEGF agents have been considered for the treatment of ROP: bevacizumab, ranibizumab, aflibercept, and conbercept, some of which are used off-label. The most commonly used is bevacizumab, a monoclonal antibody that blocks all VEGF isoforms, with a halflife of 20 days. Historically, it was the first drug to demonstrate effectiveness in treatingROP in zone I and zone II, supported by comparative studies with laser therapy, where intravitreal bevacizumab at a dose of 0.625 mg for the treatment of stage 3 ROP showed a reactivation rate of 4%, compared to 22% with laser therapy.47
Intravitreal ranibizumab has proven to be as effective as laser therapy in treating ROP in at least two major randomized clinical trials. The 2018 “CARE-ROP”48 trial compared intravitreal ranibizumab at doses of 0.2 mg and 0.12 mg with laser therapy in controlling and regressing type 1 ROP. In 2019, the “Ranibizumab versus laser therapy for the treatment of very low birthweight infants with retinopathy of prematurity (RAINBOW)”49 study, the largest randomized clinical trial conducted so far on anti-VEGF treatment in ROP, demonstrated that intravitreal ranibizumab therapy at doses of 0.2 mg and 0.1 mg was comparable to laser therapy, with even better results in terms of disease control for the 0.2 mg dose and fewer side effects in the first 24 weeks and the following two years.50 A 5-year follow-up is currently underway. It is also important to note that ranibizumab has minimal interference with systemic VEGF levels, unlike bevacizumab, which can alter serum levels for 8 to 12 weeks.51


Figure 15. Intravitreal administration of anti-VEGF drugs in a newborn in the inferotemporal quadrant using a 32-gauge, 4mm needle, at 0.75-1mm from the limbus.
A recent meta-analysis reviewed 17 studies comparing monotherapy treatment amonglaser therapy, bevacizumab, and ranibizumab: results showed similar efficacy in controlling ROP progression and inducing regression, but a higher incidence of complications and myopia associated with laser treatment.52
Aflibercept has recently received EMA approval for ROP treatment. The “FIREFLEYE”53 study, its follow-up “FIREFLEYE next”,54 and the “BUTTERFLEYE”55 study demonstrated that a dose of 0,4 mg aflibercept produced comparable results to laser therapy in terms of effectiveness and long-term disease control, with fewer long-term complications associated with laser treatment. Most children treated at 2 years not only maintained remission well but also showed good functional ability to fixate on a toy placed 5 centimeters away. They showed a lower incidence of axial myopia (-0.6 SE in the aflibercept-treated arm compared to -1.9 SE in the laser treatment arm), and a better development of peripheral retinal vascularization, which was not achievable with laser treatment. In 2019, a comparison of ranibizumab and aflibercept treatment showed fewer cases of with aflibercept compared to ranibizumab after one year.56 Currently, in China, the use of conbercept, a recombinant protein with affinity for domains 2, 3, and 4 of VEGF receptors 1 and 2, is being studied. Already approved in China for the treatment of neovascular maculopathies in adults, early studies for ROP treatment show promising, albeit still limited, results.57,58
The neonatal eye, compared to the adult eye, has several differences mainly related to its size, with a shorter axial length, developing pars plana with a potential predisposition to iatrogenic peripheral retinal breaks in case of injection. Additionally, the lens is proportionally larger than that of an adult eye. Therefore, many authors prefer to perform injections parallel to the visual axis.
Currently, there is no standardized protocol for the safe administration of intravitreal anti-VEGF in newborns with ROP. However, recent studies based on previous pediatric sclerotomy studies have proposed safety protocols that involve using sterile syringes with volumes of 1-0.5 cc, 32G needles with a length of 4mm, and injection performed in the pars plana at 0.75-1 mm posterior to the limbus in the inferotemporal quadrant, with the needle directed towards
the optic disc or along the visual axis, preceded by the administration of topical anesthetic and 5% or 10% povidone-iodine (Figure 15).59,60
As important as blocking VEGF is for controlling progression and inducing regression of ROP, it is equally important to remember that VEGF is crucial for the proper development of organs in premature infants. For this reason, studying the pharmacokinetics of anti-VEGF agents in ROP treatment is essential. The preferred method of intravitreal treatment in newborns typically involves a single that can induce regression of neovascularization without hindering the physiological development of the remaining peripheral retinal vasculature. Ideally, there should also be minimal systemic absorption, thereby minimizing the impact on the systemic VEGF activity involved in tissue development processes in premature infants. The potential interference of intravitreal anti-VEGF agents with proper postnatal development is currently debated, especially considering that prematurity, one of the most significant factors in ROP development and thus the need for anti-VEGF treatment, is also one of the most important risk factors for delayed development. Recent studies have not shown a direct and clear involvement of intravitreal anti-VEGF agents in postnatal developmental delay or deficits in premature infants treated for ROP.61
The regression of the disease presents different aspects depending on whether it is secondary to laser treatment, anti-VEGF therapy, or occurs spontaneously. It can be complete or incomplete, with or without persistence of retinal abnormalities. The initial signs of disease regression are generally vascular, with a reduction in vascular congestion or tortuosity (reduction of plus disease), and physiological vascularization may begin in the previously avascular retina (except after laser treatment). Pathological neovascular tissue becomes pale and atrophic. Other signs of regression may include involution of the tunica vasculosa lentis, resolution of retinal hemorrhages, improvement in the transparency of the dioptric media, and increased pupillary dilation. Regression results appear sooner after anti-VEGF treatment (1-3 days) compared to laser therapy (7-14 days). Persistence of the avascular peripheral retina after treatment is defined as “persistent avascular retina”.2
Disease reactivation occurs less frequently after laser therapy compared to spontaneous regressions and anti-VEGF treatment. Signs of reactivation range from the formation of a new demarcation line to the development of new neovascular lesions. Reactivation sites are usually portions of the ridge or neovascular segments. In cases of multiple reactivation sites, staging considers the most posterior portion and the term “reactivated” is applied. Long-term sequelae of ROP may include retinal detachment, retinoschisis, persistent avascular retina, foveal hypoplasia, and glaucoma.2
The utility of telemedicine is based on the advancements made in recent years in wide-field imaging and high-quality, high-resolution image acquisition. These images can be captured by properly trained technicians and uploaded online for remote consultation with specialists experienced in ROP analysis. They can also be saved and used to assess disease progression and as a research tool. The method’s utility primarily lies in its ability to be used in developing countries where ROP is prevalent, allowing for early diagnosis through remote screening to initiate necessary treatments in a timely manner. The apparent limitation related to the need for portable and suitable equipment for high-quality image acquisition and transmission has
been overcome in recent years thanks to technological advancements. Current efforts are also focused on developing analysis software to assist in ROP diagnosis and staging, as well as developing online platforms for image transmission and consultation.62-64 Ongoing studies are exploring the use of artificial intelligence through image analysis systems and deep learning, including ROPtool, Retinal ImagemultiScale Analysis, and Imaging and Informatics in Retinopathy of Prematurity (i-ROP) Research Consortium. These software systems primarily rely on measuring vascular dilation and tortuosity compared to normal values. Among these, ROPtool has shown good capabilities in identifying preplus and plus disease in both narrow-angle and wide-field imaging. Recently, the iROP software introduced the iROP ASSIST support system, which features image segmentation and merging functions, as well as automatic tracing and classification of ROP stage.65,66
In India, a telemedicine-based ROP screening system has recently been introduced, equipped with an integrated AI model for early disease detection, reporting results with a sensitivity of 100% and a specificity of 78%. The model also had the capability to integrate diagnosis and staging with clinical data such as the amount and method of oxygen administration in newborns, thus allowing for the development of new algorithms to understand and predict disease progression.67,68
The development of AI-based screening technologies, while promising, is not without potential errors, requiring lengthy training processes based on deep learning and machine learning. It is also still linked to the need for a comprehensive understanding of disease pathophysiology and potential developments, as well as issues related to medical-legal aspects.69
References
1. Terry TL. Retrolental fibroplasia. J Pediatr. 1946 Dec; 29:770-3.
2. Chiang MF, Quinn GE, Fielder AR, et al. International classification of retinopathy of prematurity, third edition. Ophthalmology. 2021;128(10):e51–e68
3. Palmer EA, Hardy RJ, Dobson V, et al. 15-year outcomes following threshold retinopathy of prematurity: final results from the multicenter trial of cryotherapy for retinopathy of prematurity. Arch Ophthalmol. 2005;123(3):311-318. doi:10.1001/archopht.123.3.311
4. Early Treatment For Retinopathy Of Prematurity Cooperative Group. Revised indications for the treatment of retinopathy of prematurity: results of the early treatment for retinopathy of prematurity randomized trial. Arch Ophthalmol. 2003;121(12):1684-1694. doi:10.1001/archopht.121.12.1684
5. Hellström A, Smith LE, Dammann O. Retinopathy of prematurity. Lancet 2013;382:1445–57.
6. Chen J, Smith LE. Retinopathy of prematurity. Angiogenesis 2007;10:133–40.
7. Hwang ES, Kassem IS, Allozi R, Kravets S, Al-Kirwi KY, Hallak JA, Costakos DM. Association between myopia progression and quantity of laser treatment for retinopathy of prematurity. PLoS One. 2022 Dec 30;17(12):e0279898. doi: 10.1371/journal. pone.0279898. PMID: 36584135; PMCID: PMC9803142.
8. Askie, L.M., Brocklehurst, P., Darlow, B.A. et al. NeOProM: Neonatal Oxygenation Prospective Meta-analysis Collaboration study protocol. BMC Pediatr 11, 6 (2011). https://doi.org/10.1186/1471-2431-11-6
9. Tarnow-Mordi W, Kirby A. Current recommendations and practice of oxygen therapy in preterm infants. Clin Perinatol. 2019;46(3):621–636
10. Kourosh Sabri, Anna L Ells, Elizabeth Y. Lee, Sourabh Dutta, Anand Vinekar; Retinopathy of Prematurity: A Global Perspective and Recent Developments. Pediatrics August 2022; 150 (3): e2021053924. 10.1542/peds.2021-053924
11. Travers CP, Clark RH, Spitzer AR, Das A, Garite TJ, Carlo WA. Exposure to any antenatal corticosteroids and outcomes in preterm infants by gestational age: prospective cohort study. BMJ. 2017;356: j1039
12. Mohsen L, Abou-Alam M, El-Dib M, Labib M, Elsada M, Aly H. A prospective study on hyperglycemia and retinopathy of prematurity. J Perinatol. 2014 Jun;34(6):453-7. doi: 10.1038/jp.2014.49. Epub 2014 Mar 27. PMID: 24674983.
13. Fonseca LT, Senna DC, Eckert GU, Silveira RC, Procianoy RS. Association between human breast milk and retinopathy of prematurity. Arq Bras Oftalmol. 2018 Apr;81(2):102-109. doi: 10.5935/0004-2749.20180024. PMID: 29846422.
14. Blencowe H, Lawn JE, Vazquez T, Fielder A, Gilbert C. Preterm-associated visual impairment and estimates of retinopathy of prematurity at regional and global levels for 2010. Pediatr Res 2013;74 Suppl 1(Suppl 1): 35–49.
15. Solebo AL, Teoh L, Rahi J. Epidemiology of blindness in children. Arch Dis Child 2017;102:853–7.
16. Gilbert C, Muhit M. Twenty years of childhood blindness: what have we learnt? Community Eye Health 2008;21:46–7.
17. Gilbert C. Retinopathy of prematurity: a global perspective of the epidemics, population of babies at risk and implications for control. Early Hum Dev 2008;84:77–82.
18. Painter SL, Wilkinson AR, Desai P, Goldacre MJ, Patel CK. Incidence and treatment of retinopathy of prematurity in England between 1990 and 2011: database study. Br J Ophthalmol 2015;99:807–11.
19. Ludwig CA, Chen TA, Hernandez-Boussard T, Moshfeghi AA, Moshfeghi DM. The epidemiology of retinopathy of prematurity in the United States. Ophthalmic Surg Lasers Imaging Retina 2017;48:553–62.
20. Kang EY, Lien R, Wang NK, Lai CC, Chen KJ, Hwang YS, et al. Retinopathy of prematurity trends in taiwan: a 10-year nationwide population study. Invest Ophthalmol Vis Sci 2018;59:3599–607.
21. Hong EH, Shin YU, Bae GH, Choi YJ, Ahn SJ, Sobrin L, et al. Nationwide incidence and treatment pattern of retinopathy of prematurity in South Korea using the 2007-2018 national health insurance claims data. Sci Rep 2021;11:1451.
22. Na KH, Kim KH, Kang TU, Hann HJ, Ahn HS, Kim HJ. Incidence, Longterm visual outcomes, and mortality in retinopathy of prematurity in Korea: a nationwide population-based study. Invest Ophthalmol Vis Sci 2020;61:14.
23. Yang Q, Zhou X, Ni Y, Shan H, Shi W, Yin X, et al. Optimised retinopathy of prematurity screening guideline in China based on a 5-year cohort study. Br J Ophthalmol 2021;105:819–23.
24. Campbell JP, Kalpathy-Cramer J, Erdogmus D, et al. Plus disease in retinopathy of prematurity: a continuous spectrum of vascular abnormality as a basis of diagnostic variability. Ophthalmology. 2016;123(11):2338e2344.
25. Wallace DK, Quinn GE, Freedman SF, Chiang MF. Agreement among pediatric ophthalmologists in diagnosing plus and preplus disease in retinopathy of prematurity. J AAPOS. 2008;12(4):352e356.
26. Reese AB, King MJ, Owens WC. Classification of retrolental fibroplasia. Am J Ophthalmol. 1953;36(10):1333e1335.
27. Hartnett ME, McColm JR. Retinal features predictive of progressive stage 4 retinopathy of prematurity. Retina. 2004;24(2):237e241.
28. Caruggi S, Scaramuzzi M, Calevo MG, et al. Validation of the postnatal growth and retinopathy of prematurity screening criteria: A retrospective Italian analysis [published online ahead of print April 22, 2021]. Eur J Ophthalmol. doi:10.1177/11206721211011362
29. Löfqvist C, Hansen-Pupp I, Andersson E, Holm K, Smith LE, Ley D, Hellström A. Validation of a new retinopathy of prematurity screening method monitoring longitudinal postnatal weight and insulinlike growth factor I. Arch Ophthalmol. 2009 May;127(5):622-7. doi: 10.1001/archophthalmol.2009.69. PMID: 19433710.
30. Binenbaum G, Ying GS, Quinn GE, Huang J, Dreiseitl S, Antigua J, Foroughi N, Abbasi S. The CHOP postnatal weight gain, birth weight, and gestational age retinopathy of prematurity risk model. Archives of Ophthalmology. 2012 Dec 1;130(12):1560-5.
31. Quinn GE, Ying GS, Bell EF, et al. ; G-ROP Study Group . Incidence and early course of retinopathy of prematurity: secondary analysis of the Postnatal Growth and Retinopathy of Prematurity (G-ROP) Study. JAMA Ophthalmol. 2018;136(12):1383-1389. doi:10.1001/jamaophthalmol.2018.4290.
32. Fierson WM; American Academy of Pediatrics Section on Ophthalmology; American Academy of Ophthalmology; American Association for Pediatric Ophthamology and Strabismus; American Association of Certified Othopists. Screening examination of premature infants for retinopathy of prematurity. Pediatrics. 2018;142(6):e20183061
33. Gunay, M., Tuten, A., Sancak, S., Celik, G., Bardak, H., Dincer, E. et al. (2016) Effect of single intravitreal bevacizumab on ophthalmic and middle cerebral arterial blood flow in retinopathy of prematurity. Ophthalmic Research, 55, 165–171.
34. Wood, E.H., Ji, M.H., Rao, P., Lertjirachai, I., Nguyen, L., Sbrocca, R.V. et al. (2021) Management of type 2 retinopathy of prematurity or less in infants aged 45 weeks postmenstrual age or older. Ophthalmic Surgery, Lasers & Imaging Retina, 52, 636–641.
35. Warren, C.C., Young, J.B., Goldberg, M.R., Connor, T.B., Kassem, I.S. & Costakos, D.M. (2018) Findings in persistent retinopathy of prematurity. Ophthalmic Surgery, Lasers & Imaging Retina,49, 497–503.
36. Kumar, P., Chandra, P., Agarwal, R., Chawla, R. & Vohra, R. (2022)Role of fluorescein angiography guided laser treatment in aggressive retinopathy of prematurity. Eye, 37, 2130–2134.
37. Jin, E., Yin, H., Liu, K., Liang, Z. & Zhao, M. (2022) Different types of hyperfluorescence observed in post anti-VEGF fluorescein angiographic patterns in retinopathy of prematurity patients. Frontiers in Medicine, 8, 800821.
38. Lepore, D., Ji, M.H., Pagliara, M.M., Lenkowicz, J., Capocchiano,N.D., Tagliaferri, L. et al. (2020) Convolutional neural network based on fluorescein angiography images for retinopathy of prematurity management. Translational Vision Science & Technology, 9, 1–8.
39. Kılıçarslan, O., Akar, S., Yılmaz Çebi, A., Hagverdiyeva, S. & Arvas, S. (2023) Evaluation of macular microvascular structure with optical coherence tomography angiography in children with history of treatment for retinopathy of prematurity. Graefe’s Archive for Clinical and Experimental Ophthalmology, 261, 651–657.)
40. Vural, A., Gunay, M., Celik, G., Demirayak, B. & Kizilay, O. (2021) Comparison of foveal optical coherence tomography angiography findings between premature children with ROP and non-premature healthy children. Eye, 35, 1721–1729.)
41. Shouchane-Blum, K., Gal-Or, O., Barayev, E., Nemet, A., Sternfeld, A., Ben Ishai, M. et al. (2022) Functional and structural findings in infants treated for retinopathy of prematurity using opticalcoherence tomography angiography.)
42. Rowe LW, Belamkar A, Antman G, Hajrasouliha AR, Harris A. Vascular imaging findings in retinopathy of prematurity. Acta Ophthalmol. 2024 Jun;102(4):e452-e472. doi: 10.1111/aos.15800. Epub 2023 Oct 24. PMID: 37874229; PMCID: PMC11039572.
43. Austeng D, Källen KBM, Ewald UW, Wallin A, Holmström GE. Treatment for retinopathy of prematurity in infants born before 27 weeks of gestation in Sweden. Br J Ophthalmol. 2010;94(9):1136–1139
44. Nicoara SD, Cristian C, Irimescu I, Stefanut AC, Zaharie G. Diode laser photocoagulation for retinopathy of prematurity: outcomes after 7 years of treatment. J Pediatr Ophthalmol Strabismus. 2014; 51(1):39–45
45. Ells AL, Gole GA, Lloyd Hildebrand P, Ingram A, Wilson CM, Geoff Williams R. Posterior to the ridge laser treatment for severe stage 3 retinopathy of prematurity. Eye (Lond). 2013;27(4):525–530
46. Wiecek E, Akula JD, Vanderveen DK, Mantagos IS, Wu C, Curran AL, De Bruyn H, Peterson B, Fulton AB. Longitudinal Change of Refractive Error in Retinopathy of Prematurity Treated With Intravitreal Bevacizumab or Laser Photocoagulation. Am J Ophthalmol. 2022 Aug;240:252-259. doi: 10.1016/j.ajo.2022.03.020. Epub 2022 Mar 31. PMID: 35367438; PMCID: PMC9308642.
47. Mintz-Hittner HA, Kennedy KA, Chuang AZ; BEAT-ROP Cooperative Group. Efficacy of intravitreal bevacizumab for stage 3+ retinopathy of prematurity. N Engl J Med. 2011;364(7):603–615
48. Stahl A, Krohne TU, Eter N, et al; Comparing Alternative Ranibizumab Dosages for Safety and Efficacy in Retinopathy of Prematurity (CARE-ROP) Study Group. Comparing alternative ranibizumab dosages for safety and efficacy in retinopathy of prematurity: a randomized clinical trial. JAMA Pediatr. 2018;172(3):278–286
49. Stahl A, Lepore D, Fielder A, et al. Ranibizumab versus laser therapy for the treatment of very low birthweight infants with retinopathy of prematurity (RAINBOW): an open-label randomised controlled trial. Lancet. 2019;394:1551e1559.
50. Marlow N, Stahl A, Lepore D, et al; RAINBOW investigators group. 2-year outcomes of ranibizumab versus laser therapy for the treatment of very low birthweight infants with retinopathy of prematurity (RAINBOW extension study): prospective follow-up of an open label, randomised controlled trial. Lancet Child Adolesc Health. 2021;5(10):698–707
51. Sato T, Wada K, Arahori H, et al. Serum concentrations of bevacizumab (avastin) and vascular endothelial growth factor in infants with retinopathy of prematurity. Am J Ophthalmol. 2012;153(2): 327–333.e1
52. Wang SD, Zhang GM; Shenzhen Screening for Retinopathy of Prematurity Cooperative Group. Laser therapy versus intravitreal injection of anti-VEGF agents in monotherapy of ROP: a meta-analysis. Int J Ophthalmol. 2020;13(5):806–815
53. Stahl A, Sukgen EA,WuWC, et al; FIREFLEYE Study Group. Effect of intravitreal aflibercept vs laser photocoagulation on treatment success of retinopathy of prematurity: the FIREFLEYE randomized clinical trial.JAMA. 2022;328(4):348-359. doi:10.1001/ jama.2022.10564
54. Stahl A, Nakanishi H, Lepore D, Wu WC, Azuma N, Jacas C, Vitti R, Athanikar A, Chu K, Iveli P, Zhao F, Leal S, Schlief S, Schmelter T, Miller T, Köfüncü E, Fielder A; FIREFLEYE next Study Group. Intravitreal Aflibercept vs Laser Therapy for Retinopathy of Prematurity: Two-Year Efficacy and Safety Outcomes in the Nonrandomized Controlled Trial FIREFLEYE next. JAMA Netw Open. 2024 Apr 1;7(4):e248383. doi: 10.1001/jamanetworkopen.2024.8383. PMID: 38687481; PMCID: PMC11061767
55. Study to assess the efficacy, safety, and tolerability of intravitreal aflibercept compared to laser photocoagulation in patients with retinopathy of prematurity (BUTTERFLEYE). ClinicalTrials.gov identifier:NCT04101721. Updated July 20, 2023
56. Sukgen EA, Koçluk Y. Comparison of clinical outcomes of intravitreal ranibizumab and aflibercept treatment for retinopathy of prematurity. Graefes Arch Clin Exp Ophthalmol. 2019;257(1):49–55
57. Li X.,Xu G.,Wang Y. et al.Safety and efficacy of conbercept in neovascular age-related macular degeneration: results from a 12-month randomized phase 2 study: AURORA study.Ophthalmology. 2014; 121: 1740-1747
58. Conbercept versus Laser for the Treatment of Infants with Zone II Retinopathy of Prematurity, Cheng, Yong et al.Ophthalmology, Volume 131, Issue 5, 636 – 638
59. Wright, Lauren M. MD*; Vrcek, Ivan M. MD†; Scribbick, Frank W. III MD*; Chang, Emmanuel Y. MD, PhD‡; Harper, C. Armitage III MD*,§. Technique for Infant Intravitreal Injection in Treatment of Retinopathy of Prematurity. Retina 37(11):p 2188-2190, November 2017. | DOI: 10.1097/IAE.0000000000001561
60. Beck KD, Rahman EZ, Ells A, Mireskandari K, Berrocal AM, Harper CA. SAFER-ROP: Updated protocol for anti-VEGF injections for retinopathy of prematurity. Ophthalmic Surg Lasers Imaging Retina 2020;51:402-6
61. Novartis Pharmaceuticals. RAINBOW extension study: an extension study to evaluate the long term efficacy and safety of ranibizumab compared with laser therapy for the treatment of infants born prematurely with retinopathy of prematurity. Available at: https://clinicaltrials.gov/ct2/show/NCT02640664
62. Jayadev C, Vinekar A, Mohanachandra P, et al. Enhancing image characteristics of retinal images of aggressive posterior retinopathy of prematurity using a novel software, (RetiView) [published online ahead of print July 9, 2015]. BioMed Res Int. doi: 10.1155/2015/898197
63. Vinekar A, Dogra MR, Jayadev C, Murthy S, Rao SV, Shetty B. Evaluation of a new, low-cost, portable, wide-field, digital, retinal camera, “Neo” for screening infants for retinopathy of prematurity – a prospective, multi-center, validation report in Asian Indian infants. Available at: https://iovs.arvojournals.org/article.aspx?articleid=2557805
64. Ryan MC, Ostmo S, Jonas K, et al. Development and evaluation of reference standards for image-based telemedicine diagnosis and clinical research studies in ophthalmology. AMIA Annu Symp Proc AMIA Symp. 2014;2014:1902–1910
65. Cabrera MT, Freedman SF, Kiely AE, Chiang MF, Wallace DK. Combining ROPtool measurements of vascular tortuosity and width to quantify plus disease in retinopathy of prematurity. J AAPOS. 2011;15(1):40–44
66. Yildiz VM, Tian P, Yildiz I, et al; Imaging and Informatics in Retinopathy of Prematurity (i-ROP) Research Consortium. Plus disease in retinopathy of prematurity: convolutional neural network performance using a combined neural network and feature extraction approach. Transl Vis Sci Technol. 2020;9(2):10
67. Campbell JP, Singh P, Redd TK, et al. Applications of artificial intelligence for retinopathy of prematurity screening. Pediatrics. 2021;147(3):e2020016618
68. Gilbert C, Malik ANJ, Vinekar A. Artificial intelligence for ROP screening and to assess quality of care: progress and challenges. Pediatrics. 2021;147(3): e2020034314
69. Ting DSW, Peng L, Varadarajan AV, et al. Deep learning in ophthalmology: the technical and clinical considerations. Prog Retin Eye Res. 2019;72:10075
Matteo Gironi, Andrea Lazzerini, Rodolfo Mastropasqua
The Vitreous accounts for 80% of the ocular globe’s volume, extending from the lens to the internal limiting membrane (ILM) of the retina. It is a gel-like substance composed of 98% water and 2% structural proteins [1,2], firmly attached to the vitreous base, the optic nerve head, the macula and the retinal vessels. Gel-liquefaction (syneresis) is the most frequent anomaly affecting the vitreous, which, associated with thickening of the collagen fibers, induces the vitreous to collapse away from the retina. Old age is the main cause of this event [3], but myopia, trauma and inflammation can precipitate this phenomenon. The separation of the vitreous cortex from the ILM is called posterior vitreous detachment (PVD). It occurs without consequences when the syneresis and the reduction of vitreoretinal adhesions at the interface are proportional between them. [4]
The prevalence of PVD increases starting from the fifth decade of life. At least in one eye, it is reported as 24% in the sixth decade and 87% in the ninth decade of life [5,6]. Autopsy studies show that PVD is present in less than 10% of people under 50 years of age but affects 27% of individuals between the age of 60 and 69 years. The rate increases to 63% over the age of 70 years [3,7]
The onset of PVD in patients with moderate or severe myopia is 5-10 years earlier than in emmetropic eyes [8]. The literature shows that the increase in axial length is positively correlated to PVD incidence and early symptoms [8,9]. Morita H et al. found that eyes longer than 30 mm have a significantly higher PVD incidence than eyes shorter than 29 mm. They also found a 12.5% prevalence of PVD in high myopic patients (axial length> 26 mm) aged between 20 and 29 years, reaching a rate of 69.4% in the 50 to 59 age group [9]
A recent observational study on 800 eyes, equally divided between genders, showed that above the age of 60 there is a faster progression of posterior vitreous detachment in women than in men [10]
Cataract surgery, inflammatory states and ocular trauma are reported as notable predisposing factors for PVD [11,12,13]
Symptoms
Floaters are the most common symptom of PVD, with a prevalence of 76% [14]
In a study of 295 patients with symptomatic PVD, Dayan at al. reported a 42% proportion of patients with floaters alone, 18% with flashes, 20.3% with both, while 19.7% reported a decrease in vision, with or without floaters and flashes [15]

Floaters are posterior vitreous opacities, perceived as mobile shadows cast from the retina, and are usually more noticeable with uniform lighting, as on a white wall. The symptomatology may appear months or years after uncomplicated PVD [16]. The most frequent cause of vitreous floaters due to PVD is the Weiss ring, which reflects the vitreous separation from the optic nerve head (Figure 1). Otherwise, floaters may suggest the presence of red blood cells, pigment cells or pigment granules in the vitreous.
Flashes are generally present when PVD occurs abruptly, and are caused by stimulation of the photoreceptors consequent to the separation of the vitreous cortex from the ILM. They are usually perceived in the temporal field of vision and are exacerbated by rapid head or eye movements [17,18] .
Patients who report symptoms of PVD require a comprehensive eye examination. Visual acuity measurement, pupillary light reaction tests, slit lamp biomicroscopy of the anterior and posterior segments and intraocular pressure (IOP) measurement should be performed. Subsequently, a thorough inspection of the vitreous and peripheral retina, performed with indirect ophthalmoscopy and scleral depression, is essential [19]
PVD is defined as complete when no attachment of the posterior vitreous cortex is found beyond the globe equator during slit lamp fundus examination. Otherwise, it is defined as partial PVD [20]
Spectral Domain-OCT can detect shallow PVD (Figure 2) that is not detectable by slit-lamp biomicroscopy, and has been used in several studies to evaluate and stage the progression [10,20,21] Ultrasound evaluation plays a key role in evaluating the vitreous and retina conditions in case of media opacity [22]
In patients with isolated PVD no treatment is required, and they are usually re-evaluated within 6 weeks from the onset of symptoms. Patients should be made aware that the symptoms may persist for longer than six months, but natural adaptation to the visual symptoms will occur over time. They should also be educated about the symptoms related to complications. Photopsies without detectable localization and influenced by eye movements suggest vitreous traction on the retina. Otherwise, repetitive phosphenes with stable localization and strong intensity may indicate the formation of a retinal tear. The rapid increase in floaters, as
well as visual field amputation, are indicative of possible serious worsening. Floaters may have a significant psychological impact on the patient, so much so that an interventional approach can be considered [23,24]. Vitrectomy via pars plana has shown to be effective in resolving patient’s discomfort [25]. Nd:YAG vitreolysis may be an alternative to surgery, but is less effective than vitrectomy [26,27]
The main purpose of PVD management is to exclude the presence of a retinal tear and establish the correct timing of the follow-up to promptly treat any potential complication.
According to the literature, in patients with acute PVD, the rate of retinal tears at presentation is generally around 10%, ranging from 8% to 47% [16,28-37] .
A prompt treatment of retinal tears associated with symptomatic PVD is strongly recommended. A systematic review by Blindbæk and Grauslund shows how the cumulative risk of retinal breaks progression to RRD varied from 2.1% to 8.8% when these are treated, but goes up to 35–47% in eyes with symptomatic, untreated retinal breaks [38]. In order to prevent the migration of vitreous fluid below the neurosensory retina, it is necessary to create a firm chorioretinal adhesion in the attached retina immediately adjacent to the lesion, using cryotherapy or laser photocoagulation. The purpose of a laser photocoagulation treatment is to surround the break with at least three rows of closely spaced laser burns. For cryopexy treatment, the tear must be completely surrounded by 2 mm of confluent cryo-burning. This is accomplished by placing the cryoprobe on the conjunctiva overlying the rupture, and cryotherapy is delivered until the retina adjacent to the rupture turns gray-white.
Van Overdam et al. through a series of two prospective studies including 520 patients, reported a 4.4% rate of new retinal breaks detected at 6-month follow-up visits [39,40]
In a retrospective case-control study and literature meta-analysis Coffee et al. found a 1.8% rate of retinal tears not detected at the first visit [29]
In a large retrospective case-control study, Uhr et al. found a delayed retinal break rate of 2.6% in patients with acute PVD. The most interesting data from this study is represented by the temporal stratification of the onset of the lesions, in fact 44,5% of the tears were detected at >6 months follow-up. They also reported a delayed detachment rate of 1%, of which 67.5% were discovered >6 weeks after presentation [37]
It is therefore recommended to follow these patients up to 6 months after the acute event [41] When vitreous syneresis happens without vitreous dehiscence, it may lead to an anomalous PVD, which is a risk factor for vitreo-macular traction, macular hole, macular pucker and retinal tears [42]
The extravasation of blood within the vitreous body is defined as vitreous hemorrhage (VH); when this does not occur as a consequence of trauma, it is defined as “spontaneous.” Since the vitreous is avascular, the bleeding comes from a retinal or uveal vessel. The most common causes include posterior vitreous detachment, with or without retinal tears, diabetic retinopathy, and retinal vascular occlusion [43,44]
The VH may arise from:
– Normal (retinal tear) or pathological (e.g. macroaneurysm) retinal vessels
– Pre-retinal or intravitreal neo-vessels (proliferative retinopathy) –
Uveal neovessels (macular degeneration).
Whatever the cause, spontaneous VH presents as a painless blurring of vision, usually unilateral and sudden. Anyway, visual symptoms range from the presence of floaters in the visual field to a profound vision loss. The visual impairment may persist for a long time until the blood reabsorbs spontaneously, and sometimes surgical removal is required. Because VH could hide a sight-threatening disease, the timing of surgery should be carefully considered. Meanwhile, the patient should be regularly monitored with ultrasound (US) investigation. Usually, vitrectomy can be postponed by 2 to 3 months if blood originates from neo-vessels, but the early vitrectomy approach seems to lead to better visual results [45]. The presence of underlying retinal tears or retinal detachment requires prompt intervention. (Figure 3, 4)


Low grade Vitreous hemorrhage (Low reflectivity)
Large retinal tear (High maximum reflectivity)
The three most common causes of VH are proliferative diabetic retinopathy (PDR) (20%- 54%), retinal tears (27%-37%) and retinal vein occlusion (RVO) (2-4%) [46,47,48]
In a prospective follow-up study, Lindgren et al. found an incidence of 7 cases of dense spontaneous VH per 100,000 population each year in Sweden, of which 41% was consequent to vitreous detachment, with or without retinal tears, 20% to PDR, 16% to RVO, 4% to age-related macular degeneration (AMD) [43]
Dana et al., in a study on 230 eyes with VH, reported an incidence of 35.2% for PDR, 18.3 for PVD and/or retinal tears, with or without retinal detachment, 7.4% for venous occlusion, 5.7% for proliferative sickle retinopathy and 2.2 % for subretinal neovascularization due to AMD. It should be highlighted that the study did not only include the causes of spontaneous VH, reporting 18.3% cases related to trauma [46]
Recently, Wang et al. reported a yearly incidence of 4.8 cases per 10,000 population for VH, of which 36.8% were possibly related to PDR, 12.4% to retinal detachment, 4.3% to AMD, and 3.7% to RVO [49]
Hypertensive retinopathy, macroaneurysm, vasculitis, blood dyscrasias, tumors and Terson’s syndrome are other, less frequent, causes of VH [46,48]. Proliferative sickle retinopathy is the leading cause of spontaneous non-diabetic vitreous hemorrhage in black patients (25% of cases). The mean age of these patients is 39 years, representing the second youngest group among non-traumatic cases [46]
Most cases of spontaneous VH are unilateral, whereas 63% of bilateral cases are associated with PDR [46]
Incidence of VH increases significantly in subjects over the age of 40 years [43, 44, 46, 47, 49]. In pediatric age, the most frequent cause of vitreous hemorrhage is represented by trauma, which accounts for 73% of cases. With a 22% of incidence, regressed ROP is the most frequent cause of spontaneous VH in this age group. Other causes are vasculitis, hematological disorders and familial exudative vitreoretinopathy (FEVR) [50,51]

Figure 5. Vitreous hemorrhage and retinal detachment due to retinal tear (B-SCAN Ultrasonography)
Vitreous hemorrhage and vitreo-retinal traction.
Retinal tear
Retinal detachment with subretinal hemorrhage
The incidence of vitreous hemorrhage, even mild, following symptomatic PVD ranges from 6 to 41% [29-34,52-54]. The reported incidence of retinal tears in patients with VH and acute PVD is between 20 and 100%, which is much higher than in PVD without VH [5,3-34,52,54,55]. The association of hemorrhagic PVD and frank retinal detachment is less frequent and there is no agreement among experts regarding its incidence rate. (Figure 5)
Sarrafizadeh et al. showed that patients with a history of retinal detachment have a significantly higher risk of developing a retinal detachment in the fellow eye in case of acute hemorrhagic PVD [56]
Symptoms
Patients with intravitreal bleeding usually experience sudden symptoms, such as shadows, floaters, flashes and visual haze. Visual haze, with or without floaters, is the more frequent symptom, while photopsia has only been reported in association with PVD with or without a retinal tear [52]
The patients describe floaters as “numerous” or “too many to count” suggesting that red blood cells are present in the vitreous. Visual field amputation could be a sign of retinal detachment, but it is well recognizable at physical examination only in mild or moderate VH. When the amount of blood in the vitreous is large, visual haze can be significant. Thompson et al. have shown that 12.5 μl of blood diluted in the 5-ml is sufficient to reduce visual acuity to hand motion or worse, but vitreous hemorrhage is never associated with complete loss of vision [57]. In dense vitreous hemorrhage, it is very important to evaluate light perception. A perfectly oriented perception of light is not usually related to a large retinal detachment.
A complete, bilateral and comparative ophthalmological evaluation should be performed in patients presenting symptoms suggestive of vitreous hemorrhage. On physical examination, the anterior segment is often unremarkable even though blood cells can sometimes be found in the anterior chamber. It is also necessary to evaluate signs of comorbidities. IOP should also be assessed. An asymmetrical IOP below 10 mmHg should suggest the onset of a retinal detachment, which on the contrary, is rare when IOP is high. Depending on the severity of the VH, fundus examination may not always be possible. There is no uniformity in the evaluation of VH, because there is no standardized rating scale, and the evaluation is usually subjective. Lieberman et al. proposed a grading scale based on the number of visible retinal clock hours [58]. In clinical practice, grading is frequently based on Tyndall (e.g. 1+ to 4+) and the presence, or absence, of the red reflex. A practical and useful evaluation of the intensity of vitreous hemorrhage must consider different grades:
• Grade 0: No bleeding
• Grade 1: Mild or moderate bleeding, which allows fundus exploration and laser treatment;
• Grade 2: Moderate or severe bleeding, which allows sufficient exploration of the retina, but not the laser treatment posterior to the equator;
• Grade 3: Dense hemorrhage without any optical access to the posterior pole, but red reflex is visible;
• Grade 4: No red reflex.
If the VH is too dense to allow a correct assessment of the fundus, the first step is to perform ultrasound investigation. In a non-pathological eye, the vitreous cavity appears as hypoechoic, surrounded by a hyperechoic retina indistinguishable from the underlying hyperechoic choroid.
Ultrasound analysis allows us to evaluate the severity of VH and detect the presence of PVD, retinal tears, retinal detachment, fibrovascular proliferations, macular degeneration and tumors. (Figure 6-9)
The exploration must proceed quadrant by quadrant at different gain levels to evaluate any anomalies in the vitreous cavity, in the retinal layer and in the choroid layer. It is essential to end the ultrasound examination with dynamic analysis.
The role of ultrasound examination is fundamental in assessing retinal tears or retinal detachment, which greatly influences management.
DiBernardo C. et al. showed a high accuracy of the US investigation in detecting small retinal tears in VH, with a sensitivity of 91% and specificity of 97% [59]. Rabinowitz R. et al. reported a sensitivity of 100% of the US for the RD identification with a specificity of 91%, which relates to 18% false positives. Otherwise, they reported a sensitivity of 44% for retinal tears, compared to an excellent specificity (97%) [60]
Laboratory tests such as blood glucose, complete blood count, bleeding and clotting time and platelet count are also often indicated.
At the base of the VH management strategies, there is a correct recognition of the underlying disease and the identification of potential complications, such as retinal tears, retinal detachment (rhegmatogenous, tractional, or a combination of both), neovascular glaucoma, ghost cell glaucoma.

Figure 6. Recent vitreous hemorrhage with complete vitreous detachment (B-SCAN Ultrasonography).
Anterior vitreous hemorrhage (Low-medium reflectivity)
Retrohyaloideal bleeding (Low reflectivity)

Figure 7. Partial vitreous hemorrhage with retrohyaloideal blood (B-SCAN Ultrasonography).
Retrohyalideal vitreous hemorrhage (Low-medium reflectivity)

8. Low grade hemorrhage due to retinal tear (B-SCAN Ultrasonography)
Large retinal tear (High reflectivity)

Figure 9. Retinal tear with narrow retinal detachment (B-SCAN Ultrasonography).
Vitreous hemorrhage (Low-medium reflectivity)
Retinal tear and narrow retinal detachment (High reflectivity)
Historically, a vitreous hemorrhage of unknown cause was approached in a conservative fashion. Head elevation combined with immobilization, possibly associated with bilateral patch, was recommended to allow for faster clearance of blood in the superior vitreous cavity. In these conditions, both in the United Kingdom and in the United States, most ophthalmologists preferred to wait for spontaneous resolution of the hemorrhage [61,62]
It is crucial to modulate the therapeutic approach based on the cause of the bleeding.
• Vitreous Hemorrhage with Posterior Vitreous Detachment with or without Retinal Tears
In mild to moderate bleeding cases following PVD, it is usually possible to identify and treat most retinal tears with cryopexy and laser. (Figure 10). The current literature reports that retinal tears after PVD are more frequently located in the upper quadrants [56,59,63,64]
Cases of dense vitreous hemorrhage associated with acute PVD are challenging. It is not easy to detect or rule out the presence of a retinal tear. In some cases, indirect examination with scleral indentation is crucial to rule out rhegmatogenous lesions. Nevertheless, a close follow up with US is strongly recommended.
Surgery in patients with dense VH is often performed when a retinal tear or retinal detachment is observed, or if the bleeding does not resolve spontaneously after a waiting period, sometimes up to 3 months. The main complication related to waiting for surgery is the onset of PVR which seriously compromises the visual outcome [56,65,66]
It is important to highlight the possibility that retinal tears may not be identified on a US investigation, and this could lead to retinal detachment during the follow-up. Sensitivity of retinal break detection appears to be >90% in small series studies, but decreases to under 60% in publications with a higher sample size [47,59,60,63]
Due to the high risk of severe visual acuity impairment, some authors recommend early explorative vitrectomy in dense VH with PVD [64,67] .
• Proliferative diabetic retinopathy
In VH associated with diabetic retinopathy, the therapeutic approach depends primarily on the intensity of the bleeding and the risk of clinical deterioration. When the bleeding does not compromise the ability to perform laser treatment, panretinal photocoagulation (PRP) is the gold-standard treatment in absence of macular traction [68,69]


Early vitrectomy is indicated, within 15 days, when iris rubeosis or active tractions with retinal detachment are found (Figure 11) [70,71]
Vitrectomy, along with panretinal photocoagulation, is indicated within 6 weeks when subjects have not previously been treated with PRP, have type 1 diabetes, or in presence of functional impairment of the fellow eye [70,72]. In type 2 diabetic patients, the advantages of early vitrectomy on long-term visual prognosis has not been demonstrated [71] . In the absence of these conditions, surgery can be replaced by an observational approach, with close follow-up. Surgery will be required if the bleeding does not resolve within 2-3 months or sooner if complications are found during follow-up visits. In patients with diabetic retinopathy and VH requiring vitrectomy, surgery is often associated with perioperative intravitreal injection of anti-VEGF. This reduces the risk of postoperative bleeding [73]. Furthermore, when performed preoperatively (1 to 7 days prior), the anti-VEGF injection reduces the risk of intraoperative complications by facilitating surgical maneuvers [74]
The early recognition and management of vein occlusion related VH is critically important, and a delayed diagnosis can be detrimental. Vitreous hemorrhage is more frequent in BRVO than in CRVO. In addition, recurrent hemorrhages were noted in 28% of cases of BRVO [75]
In accordance with the Central Vein Occlusion Study and the Branch Vein Occlusion Study, photocoagulation must be promptly performed in the presence of neo-vessels to prevent VH and/or neovascular glaucoma [76,77]
In cases where VH persists beyond 1 to 3 months of follow-up, vitrectomy associated with sectoral or panretinal photocoagulation is recommended. In a retrospective study on patients with VH and CRVO, Chaung et al. found a considerable gain, both in terms of visual improvement and development of NVG in eyes treated with complete PPV and PRP compared to patients treated by PRP alone [78]
In a retrospective study on 88 eyes with dense VH, Mayuka Hayashida et al. found no statistical difference in BCVA at >1 month follow-up in patients with RVO treated with early-vitrectomy (<2 weeks), compared to those undergoing delayed surgery after 2 weeks. Nonetheless, early surgery can be helpful in preventing disease progression or performing photocoagulation treatment [79]
References
1. Wilkinson C., Hinton D., Sadda S., Wiedemann P. Ryan’s Retina Sixth Edition. Elsevier Health Sciences; 2017
2. Bishop PB. Vitreous proteins. Sebag J. Vitreous – in Health and Disease. Springer: New York; 2014:3–13.
3. Foos RY, Wheeler NC. Vitreoretinal juncture: synchysis senilis and posterior vitreous detachment. Ophthalmology. 1982;89:1502–1512.
4. Foos RY. Ultrastructural features of posterior vitreous detachment. Graefes Arch Clin Exp Ophthalmol. 1975;196:103– 111.
5. Hollands H, Johnson D, Brox AC, Almeida D, Simel DL, Sharma S. Acute-onset floaters and flashes: is this patient at risk for retinal detachment? JAMA. 2009;302(20):2243–2249.
6. Rahman R, Ikram K, Rosen PH, Cortina-Borja M, Taylor ME. Do climatic variables influence the development of posterior vitreous detachment? Br J Ophthalmol. 2002;86(7):829.
7. Foos RY. Posterior vitreous detachment. Trans Am Acad Ophthalmol Otolaryngol. 1972 Mar-Apr;76(2):480-97. PMID: 4582684.
8. Akiba J. Prevalence of posterior vitreous detachment in high myopia. Ophthalmology. 1993 Sep;100(9):1384-8. doi: 10.1016/ s0161-6420(93)31471-5. PMID: 8371928.
9. Morita H, Funata M, Tokoro T. A clinical study of the development of posterior vitreous detachment in high myopia. Retina. 1995;15(2):117-24.
10. Hayashi K, Sato T, Manabe SI, Hirata A. Sex-Related Differences in the Progression of Posterior Vitreous Detachment with Age. Ophthalmol Retina. 2019 Mar;3(3):237-243.
11. Coppé AM, Lapucci G. Posterior vitreous detachment and retinal detachment following cataract extraction. Curr Opin Ophthalmol. 2008 May;19(3):239-42.
12. Hogan MJ. Inflammation and its effect on the vitreous. Trans Ophthalmol Soc U K. 1975;95(3):378-81. PMID: 1066854.
13. Hsu HT, Patterson R, Ryan SJ. Traumatic posterior vitreous detachment: scanning electron microscopy of an experimental model in the monkey eye. Scan Electron Microsc. 1984;(Pt 3):1361-8. PMID: 6438790.
14. Webb BF, Webb JR, Schroeder MC, North CS. Prevalence of vitreous floaters in a community sample of smartphone users. Int J Ophthalmol. 2013;6(3):402–405.
15. Dayan MR, Jayamanne DG, Andrews RM, Griffiths PG. Flashes and floaters as predictors of vitreoretinal pathology: is follow-up necesary for posterior vitreous detachment? Eye (Lond). 1996;10(Pt 4): 456–458.
16. Johnson MW. Posterior vitreous detachment: evolution and complications of its early stages. Am J Ophthalmol. 2010;149(3):371–382.
17. Brown GC, Brown MM, Fischer DH. Photopsias: A Key to Diagnosis. Ophthalmology. 2015 Oct;122(10):2084-94.
18. Milston R, Madigan MC, Sebag J. Vitreous floaters: Etiology, diagnostics, and management. Surv Ophthalmol. 2016 MarApr;61(2):211-27.
19. Natkunarajah M, Goldsmith C, Goble R. Diagnostic effectiveness of noncontact slitlamp examination in the identification of retinal tears. Eye. 2003;17(5):607-609.
20. Kakehashi A, Takezawa M, Akiba J. Classification of posterior vitreous detachment. Clin Ophthalmol. 2014;8:1-10.
21. Uchino E, Uemura A, Ohba N. Initial stages of posterior vitreous detachment in healthy eyes of older persons evaluated by optical coherence tomography. Arch Ophthalmol. 2001 Oct;119(10):1475-9.
22. Zvornicanin J, Jusufovic V, Cabric E, Musanovic Z, Zvornicanin E, Popovic-Beganovic A. Significance of ultrasonography in evaluation of vitreo-retinal pathologies. Med Arch. 2012;66(5):318-20
23. Kim YK, Moon SY, Yim KM, Seong SJ, Hwang JY, Park SP. Psychological Distress in Patients with Symptomatic Vitreous Floaters. J Ophthalmol. 2017;2017:3191576.
24. Garcia GA, Khoshnevis M, Yee KMP, Nguyen-Cuu J, Nguyen JH, Sebag J. Degradation of contrast sensitivity function following posterior vitreous detachment. Am J Ophthalmol. 2016;172:7-12.
25. Sebag J, Yee KM, Wa CA, Huang LC, Sadun AA. Vitrectomy for floaters: prospective efficacy analyses and retrospective safety profile. Retina. 2014;34(6):1062-1068.
26. Delaney YM, Oyinloye A, Benjamin L. Nd:YAG vitreolysis and pars plana vitrectomy: surgical treatment for vitreous floaters. Eye (Lond). 2002 Jan;16(1):21-6.
27. Kokavec J, Wu Z, Sherwin JC, Ang AJ, Ang GS. Nd:YAG laser vitreolysis versus pars plana vitrectomy for vitreous floaters. Cochrane Database Syst Rev. 2017 Jun 1;6(6):CD011676.
28. Linder B. Acute posterior vitreous detachment and its retinal complications: a clinical biomicroscopic study. Acta Ophthalmol 1966;87:S1–S108.
29. Coffee RE, Westfall AC, Davis GH, Mieler WF, Holz ER. Symptomatic posterior vitreous detachment and the incidence of delayed retinal breaks: case series and meta-analysis. Am J Ophthalmol. 2007; 144(3):409–413.
30. Jaffe NS (1968) Complications of acute posterior vitreous detachment. Arch Ophthalmol 79:568–571
31. Kanski JJ (1975) Complications of acute posterior vitreous detachment. Am J Ophthalmol 80:44–46
32. Tabotabo MM, Karp LA, Benson WE (1980) Posterior vitreous detachment. Ann Ophthalmol 12:59–61
33. Novak MA, Welch RB (1984) Complications of acute symptomatic posterior vitreous detachment. Am J Ophthalmol 97:308–314
34. Byer NE (1994) Natural history of posterior vitreous detachment with early management as the premier line of defence against retinal detachment. Ophthalmology 101:1503–1514
35. Tasman WS. Posterior vitreous detachment and peripheral retinal breaks. Trans Am Acad Ophthalmol Otolaryngol 1968;72:217–224.
36. Richardson PS, Benson MT, Kirkby GR. The posterior vitreous detachment clinic: do new retinal breaks develop in the six weeks following an isolated symptomatic posterior vitreous detachment? Eye 1999;13:237–240
37. Uhr JH, Obeid A, Wibbelsman TD, Wu CM, Levin HJ, Garrigan H, Spirn MJ, Chiang A, Sivalingam A, Hsu J. Delayed Retinal Breaks and Detachments after Acute Posterior Vitreous Detachment. Ophthalmology. 2020 Apr;127(4):516-522.
38. Blindbaek S, Grauslund J. Prophylactic treatment of retinal breaks- a systematic review. Acta Ophthalmol. 2015 Feb;93(1):3-8. doi: 10.1111/aos.12447. Epub 2014 May 22. PMID: 24853827.
39. van Overdam KA, Bettink-Remeijer MW, Mulder PG, van Meurs JC. Symptoms predictive for the later development of retinal breaks. Arch Ophthalmol. 2001;119(10):1483-1486.
40. van Overdam KA, Bettink-Remeijer MW, Klaver CC, Mulder PG, Moll AC, van Meurs JC. Symptoms and findings predictive for the development of new retinal breaks. Arch Ophthalmol. 2005;123(4):479-484
41. Davis MD. Natural history of retinal breaks without detachment. Arch Ophthalmol. 1974 Sep;92(3):183-94.
42. Sebag J. Anomalous posterior vitreous detachment: A unifying concept in vitreoretinal disease. Graefes Arch Clin Exp Ophthalmol 2004;242:690 – 698.
43. Lindgren G, Sjodell L, Lindblom B. A prospective study of dense spontaneous vitreous hemorrhage. Am J Ophthalmol 1995;119(4):458-465.
44. Butner RW, McPherson AR. Spontaneous vitreous hemorrhage. Surv Ophthalmol 1982;14(3):268-270.
45. Sato T, Morita S, Bando H, Sato S, Ikeda T, Emi K. Early vitreous hemorrhage after vitrectomy with preoperative intravitreal bevacizumab for proliferative diabetic retinopathy. Middle East Afr J Ophthalmol 2013;20(1):51-55.
46. Dana MR, Werner MS, Viana MA, Shapiro MJ. Spontaneous and traumatic vitreous hemorrhage. Ophthalmology 1993; 100(9):1377-1383.
47. Morse PH, Aminlari A, Scheie HG. Spontaneous Vitreous Hemorrhage. Arch Ophthalmol. 1974;92(4):297–298. Spraul CW, Grossniklaus HE. Vitreous Hem- orrhage. Surv Ophthalmol. 1997 Jul-Aug; 42(1):3–39
48. Wang CY, Cheang WM, Hwang DK, Lin CH. Vitreous haemorrhage: a population-based study of the incidence and risk factors in Taiwan. Int J Ophthalmol 2017;10(3):461-466
49. Spirn MJ, Lynn MJ, Hubbard GB 3rd. Vitreous hemorrhage in children. Ophthalmology. 2006 May;113(5):848-52
50. Sudhalkar A, Chhablani J, Jalali S, Mathai A, Pathengay A. Spontaneous vitreous hemorrhage in children. Am J Ophthalmol. 2013 Dec;156(6):1267-1271.e2
51. Bond-Taylor M, Jakobsson G, Zetterberg M. Posterior vitreous detachment - prevalence of and risk factors for retinal tears. Clin Ophthalmol. 2017;11:1689-1695. Published 2017 Sep 18. doi:10.2147/OPTH.S143898
52. Boldrey EE (1983) Risk of retinal tears in patients with vitreous floaters. Am J Ophthalmol 96:783–787
53. Murakami K, Jalkh AE, Avila MP, Trempe CL, Schepens CL (1983) Vitreous floaters. Ophthalmology 90:1271–1276 Sharma S, Walker R, Brown GC, Cruess AF. The importance of qualitative vitreous examination in patients with acute posterior vitreous detachment. Arch Ophthalmol 1999;117: 343– 6.
54. Sarrafizadeh R, Hassan TS, Ruby AJ, et al. Incidence of retinal detachment and visual outcome in eyes presenting with posterior vitreous separation and dense fundus- obscuring vitreous hemorrhage. Ophthalmology 2001;108(12): 2273–2278.
55. Thompson JT, Stoessel KM. An analysis of the effect of intravitreal blood on visual acuity. Am J Ophthalmol. 1987 Oct 15; 104(4):353-7 doi: 10.1016/0002-9394(87)90224-8 PMID: 3661644.
56. Lieberman RM, Gow JA, Grill LR. Development and implementation of a vitreous hemorrhage grading scale. Retin Physician 2006.
57. DiBernardo C, Blodi B, Byrne SF (1992) Echographic evaluation of reti- nal tears in patients with spontaneous vitreous haemorrhage. Arch Ophthal- mol 110:511–514
58. Rabinowitz R, Yagev R, Shoham A, Lifshitz T. Comparison between clinical and ultrasound findings in patients with vitreous hemorrhage. Eye (Lond). 2004 Mar;18(3):253-6. doi: 10.1038/sj.eye.6700632. PMID: 15004573.
59. Vote BJ, Membrey WL, Casswell AG. Vitreous haemorrhage without obvious cause: national survey of management practices. Eye 2005;19(7):770–777.
60. Preferred Practice Pattern. Management of Posterior Vitreous Detachment, Retinal Breaks, and Lattice Degeneration. San Francisco: American Academy of Ophthalmology; 2008.
61. Nischal KK, James JN, McAllister J. The use of dynamic ultrasound B-scan to detect retinal tears in spontaneous vitreous haemorrhage. Eye 1995;9(4):502–506.
62. Tan HS, Mura M, Bijl HM. Early vitrectomy for vitreous hemorrhage associated with retinal tears. Am J Ophthalmol. 2010 Oct;150(4):529-33.
63. Seelenfreund MH, Sternberg I, Hirsch I, Silverstone BZ (1983) Retinal tears with total vitreous hemorrhage. Am J Ophthalmol 95:659–662
64. Katsumi O, Hirose T, Kruger-Leite E, Kozlowski I, Tanino T (1989) Diagno- sis and management of massive vitre- ous haemorrhage caused by retinal tear. Jpn J Ophthalmol 33:177–184
65. Dhingra N, Pearce I, Wong D. Early vitrectomy for fundus- obscuring dense vitreous haemorrhage from presumptive retinal tears. Graefes Arch Clin Exp Ophthalmol 2007;245(2):301– 304.
66. Photocoagulation treatment of proliferative diabetic retinopathy. Clinical application of Diabetic Retinopathy Study (DRS) findings, DRS Report Number 8. The Diabetic Retinopathy Study Research Group. Ophthalmology. 1981 Jul;88(7):583-600.
67. Early Treatment Diabetic Retinopathy Study design and baseline patient characteristics. ETDRS report number 7. Ophthalmology. 1991 May;98(5 Suppl):741-56.
68. Smiddy WE, Flynn Jr HW. Vitrectomy in the management of diabetic retinopathy. Surv Ophthalmol 1999;43:491—507.
69. Early vitrectomy for severe vitreous hemorrhage in diabetic retinopathy. Four-year results of a randomized trial: Diabetic Retinopathy Vitrectomy Study Report 5. Arch Ophthalmol 1990;108:958—64.
70. Early vitrectomy for severe proliferative diabetic retinopathy in eyes with useful vision. Results of a randomized trial--Diabetic Retinopathy Vitrectomy Study Report 3. The Diabetic Retinopathy Vitrectomy Study Research Group. Ophthalmology. 1988 Oct;95(10):1307-20.
71. Ahmadieh H, Shoeibi N, Entezari M, Monshizadeh R. Intra- vitreal bevacizumab for prevention of early postvitrectomy hemorrhage in diabetic patients: a randomized clinical trial. Ophthalmology 2009;116:1943—8.
72. Zhao LQ, Zhu H, Zhao PQ, Hu YQ. A systematic review and meta-analysis of clinical outcomes of vitrectomy with or without intravitreal bevacizumab pretreatment for severe dia- betic retinopathy. Br J Ophthalmol 2011;95:1216—22.
73. Hayreh SS, Rubenstein L, Podhajsky P. Argon laser scatter photocoagulation in treatment of branch retinal vein occlusion. A prospective clinical trial. Ophthalmologica. 1993;206(1):1-14.
74. Central vein occlusion study of photocoagulation therapy. Baseline findings. Central Vein Occlusion Study Group. Online J Curr Clin Trials. 1993 Oct 14
75. Argon laser scatter photocoagulation for prevention of neovascularization and vitreous hemorrhage in branch vein occlusion. A randomized clinical trial. Branch Vein Occlusion Study Group. Arch Ophthalmol. 1986 Jan;104(1):34-41.
76. Chuang LH, Wang NK, Chen YP, Yeung L, Hwang YS, Chen KJ, Wu WC, Chen TL, Lai CC. Vitrectomy and panretinal photocoagulation reduces the occurrence of neovascular glaucoma in central retinal vein occlusion with vitreous hemorrhage. Retina. 2013 Apr;33(4):798-802.
77. Hayashida M, Miki A, Imai H, Otsuka K, Azumi A, Nakamura M. Impact of Early Vitrectomy for Dense Vitreous Hemorrhage of Unknown Etiology. Ophthalmologica. 2019;242(4):234-238. doi: 10.1159/000501723. Epub 2019 Sep 3. PMID: 31480058.
Francesco Boscia, Giancarlo Sborgia
Vitreomacular traction syndrome is a significant disorder of the vitreoretinal interface. It is characterized by an incomplete posterior vitreous detachment, with the remaining adherent vitreous exerting a traction on the macula, that eventually leads to morphologic alteration and consequent functional decline of vision.
It is possible to identify two major appearances of this pathology: Vitreomacular adhesion (VMA) and Vitreomacular traction (VMT).
Vitreomacular adhesion (VMA) is an attachment of the posterior cortical vitreous to the macula without a resulting traction. Vitreomacular traction (VMT) occurs when the posterior cortical vitreous partially separates from the retina with some areas of adhesion still remaining and exerting tractional forces on the neurosensory retina.
Historically the vitreomacular interface has been studied with the biomicroscope or the stereoscopic fundus photography. Therefore it was difficult to determine some abnormalities. In fact, evaluating these abnormalities only with the slit lamp could lead to an underestimation of the vitreomacular interface alterations due to the grades of vitreous clarity and the examinator ability.1 The advent of the SD-OCT has led to a significant improvement in detecting, studying and monitoring the progression of the VM interface pathologies.2
As far as risk factors are concerned, it is possible to divide them into two groups: non modifiable and modifiable risk factors. As shown in several studies, aging represents the major non modifiable risk factor for the VMT because of the physiological modifications of the vitreous that can result in VM alterations.
VMT is more prevalent in elderly people, with 0.4-2% of the US population affected by the pathology older than 63 years old.3
It has been demonstrated that the higher incidence is in elderly women after menopause, probably because of the lack of the estrogen protective effect on the connective tissue in the vitreous gel.4
Other non modifiable risk factors are high myopia, exudative age-related macular degeneration, diabetic macular edema, retinal vein occlusion and diabetic retinopathy. The modifiable risk factors are ocular trauma and vitreoretinal surgery. Depending on the compresence of other macular disease, e.g. AMD, RVO, DR, VMT is classified as concurrent or isolated.
In adults, the vitreous is composed of 98% water and 2% structural macromolecules5 forming a 4 ml clear, gel-like structure. The vitreous body is contained within a cortex composed of a dense collagen matrix. The posterior vitreous cortex and retinal ILM are bounded at their interface by a macromolecular attachment complex, which is composed of fibronectin, laminin, and other extracellular components that form a glue-like matrix.
Posterior vitreous detachment (PVD) is the result of a complex and inevitable set of events that occurs as the eye ages. It manifests as gel liquefaction and weakening of vitreoretinal adhesion. Over decades during midlife, there is concurrent liquefaction of the gel (synchysis), the collagen fibrillar aggregation (syneresis) and the progressive posterior vitreous cortex separation, ultimately leading to non-pathologic PVD in most eyes. OCT scans reveal that PVD usually begins in the perifoveal macula.
Typically, concurrent vitreoretinal separation initiates at multiple sites throughout the peripheral fundus as well, and the process proceeds for years or decades before coalescing into a final separation of the vitreous from the macula and the optic nerve, resulting in a complete PVD. The completion of vitreopapillary separation, often indicated by the appearance of the Weiss ring, is the acute and often symptomatic culmination of a long lasting process. Inadequate or incomplete vitreoretinal interface separation can result in anomalous PVD with the potential for consequentiality of the VMI.
Partial vitreoretinal separation is almost an inevitable stage throughout this process. However, in cases where liquefaction or contraction of the vitreous gel outpaces the detachment of the vitreous cortex, or where there is an abnormal adhesion of the vitreous cortex to the ILM - or a combination of both - a range of anomalous macular conditions can arise varying depending on the strength and location of the remaining attachments.6 The result of this mismatch is an anomalous PVD, defined as a partial detachment of the vitreous with persistent attachment in the macular region, characterized by an abnormal adhesion to one or more structures in the posterior pole, leading to tractional deformation of the retinal tissue.
Local anatomic ocular variations, as seen in high myopia, or extrinsic forces such as blunt trauma or intraocular surgery, can also play a role.
Anomalous DPV can lead to a partial dehiscence of the vitreous, resulting in an adhesion in the perifoveal area that causes an antero-posterior traction. Is it known that the vitreous is more firmly attached to the retina in areas where the ILM is thinner, such as the vitreous base and the posterior pole.6-8 In fact, according to Uchino’s PVD classification,8 these are the last areas where the detachment occurs. This easily explains why the anomalous persistence of adhesion between vitreous and fovea and the antero-posterior traction caused by the syneresis results in foveal elevation or distortion in VMT.9 Moreover, ocular saccades cause a dynamic anterior traction at the site of vitreofoveal attachment, causing macular distortion or disruption. The area of the attachment plays an important role in the modification of the retinal layers. The thinner is the VMT, the more powerful is the tractional force on the fovea. The strength of the traction depends on the extent of vitreous attachment: when it is focal, the angle of the vector is more perpendicular to the retinal surface, resulting in a greater traction force, which leads to distortion of the foveal surface and the formation of pseudocysts within the central macula.10 In the broad type, the traction force causes generalized thickening of the macula, macular schisis, cystoid macular edema


and vascular leakage on fluorescein angiography.8 With the progression of PVD, even in the absence of a Weiss ring, residual vitreous tissue often remains on the inner retinal surface. Autopsy studies reveal that vitreous remnants persist on the retinal surface in nearly half of all eyes with PVD. This condition is called vitreoschisis. This residual vitreous may proliferate to form an epiretinal membrane (ERM) at any stage of vitreous separation. (Figure 1).
Other possible complications are a full-thickness macular hole, an anatomical defect in the fovea characterized by the interruption of all neural retinal layers from the ILM to the RPE, and the Lamellar macular hole (Figure 2), a partial-thickness foveal defect.
Vitreomacular traction syndrome is now considered a spectrum of disorders which induce secondary pathologies. These conditions include macular holes, cystoid macular edema, epiretinal membranes and retinoschisis.
History
As the first step in patients with suspected VMT, a thorough medical history is required, which should include the duration and type of symptoms, and the ophthalmological history:
• Glaucoma or other disorders
• Traumatic injuries
• Surgery or any other treatment
• Use of medications that are potentially related to the development of macular cysts (eg, systemic niacin, topical prostaglandin analogues)3,11
Symptoms
VMAs generally do not cause a decrease in visual acuity or any other symptoms and can be considered a normal finding in the natural course of PVD. Other disorders of the Vitreomacular traction syndrome may present with:
• a decrease in visual acuity
• metamorphopsia
• micropsia or macropsia
• photopsia.
In VMT syndrome, the onset of symptoms is gradual, and when the vitreous detaches from the retina, it can cause tractional foveal distortion, cystoid macular edema and, in more severe cases, tractional macular detachment.12 However, even in patients with apparent VMT symptoms, they may be absent.
Signs and physical examination
Slit lamp examination with macular lenses is essential for an accurate diagnosis and the start of further workup. Fundus examination may reveal a translucent glistening membrane adhering to the macula.13
The course of retinal vessels may be distorted from tractional changes. The absence of a Weiss ring can be useful in excluding other pathological conditions, such as grade IV FTMH. Additionally, the Watzke-Allen test and Amsler grid test can be easily performed by the physician for differential diagnosis.
Diagnosis is challenging if based solely on the clinical examination and should be made in conjunction with OCT imaging.
Although VMTS has been recognized by ophthalmologists for decades, we are now able to examine and classify it with the help of OCT imaging. OCT is the most accurate method for visualizing the Vitreoretinal interface; in recent years, OCT technology has improved and become more widely available, providing images with even higher resolution, and reducing artifacts produced by motion.
Vitreomacular adhesion (Figure 3) is a detachment of the perifoveal vitreous from the retinal surface without any retinal abnormalities; it can be considered a normal condition as most eyes can have complete vitreoretinal adhesion at birth. VMA represents a specific stage of vitreous separation where there has been a partial detachment of the vitreous in the perifoveal area without any detectable change in the foveal contour or the underlying retinal tissues. Vitreomacular adhesion is characterized by an elevation of the cortical vitreous above the

retinal surface, with the vitreous remaining attached within a 3-mm radius of the fovea (arbitrarily defined). The main characteristics are:
• The angle between the vitreous and the inner retinal surface is acute.
• The retina displays no change in contour or morphologic features on OCT because of the vitreous adhesion.
With time, the vitreous may separate spontaneously from the inner retina, usually without incident.
With time, the vitreous may separate spontaneously from the inner retina, usually without incident. VMA can be classified by size of the adhesion into:
• Focal: ≤ 1500 μm
• Broad: > 1500 μm
This 1500-μm diameter is a known area of greater vitreous adhesion to the fovea. Additionally, this figure has been commonly used to distinguish focal VMA from broad VMA in the published vitreoretinal literature and most OCT reading centers; although it is not clear whether there is any prognostic difference between focal and broad VMA.
VMA can be classified by the presence of concurrent retinal conditions in:
• Concurrent, when associated with macular abnormalities as age-related macular degeneration, retinal vein occlusion, or diabetic macular edema.
• Isolated, when no ocular disease is present.
The evolution of VMA can lead to periods of excessive traction on the macula. This condition is defined as vitreomacular traction (VMT) and involves anatomical changes in the contour of the foveal surface (Figure 4), intraretinal pseudocyst formation, elevation of the fovea from the RPE with subretinal fluid, macular schisis, or a combination that typically results in reduced or distorted vision. All these anatomical changes are detectable by OCT, which is the gold standard for diagnosis, just as with VMA.
The anatomical criteria, defined by the IVMTS Group, that must appear on at least one B-mode OCT scan to classify an eye as affected by VMT are:
• Evidence of perifoveal vitreous cortex detachment from the retinal surface;
• Vitreous cortex attachment to the macula within a 3-mm radius from the fovea
• Association of attachment with foveal surface distortion, intraretinal structural changes, foveal elevation above the RPE, or a combination of these, but no full-thickness interruption of all retinal layers.8
OCT scans also allow for various types of classifications: by size, by the presence of concur-
rent retinal conditions, and other customized categorizations proposed by different authors that will be discussed later.
Like VMA, VMT can be classified on the extent of vitreous attachment into:
Focal ≤ 1500 μm. They tend to distort the foveal surface, elevate the foveal floor, form pseudocysts within the central macula, or cause a combination of these effects. The presence of pseudocysts is usually linked with diminished visual acuity and visual distortion. Following the release of traction, pseudocysts typically resolve over time, leaving only a minor visual deficit
• Broad > 1500 μm. It can cause generalized macular thickening, vascular leakage on fluorescein angiography, macular schisis, and cystoid macular edema.
Moreover, VMT can be classified by the presence of concurrent retinal conditions in:
• Concurrent, when associated with other macular conditions
• Isolated, when no other ocular disease is present.
John et al. also described a system for cataloging the intraretinal OCT findings at presentation 14
• Grade 1: Incomplete cortical vitreous separation with foveal attachment
• Grade 2: Grade 1 + Presence of intraretinal cysts/clefts
• Grade 3: Grade 2 + Foveal photoreceptors detachment.
Sonmez et al. suggested that the severity of the foveal deformation may be associated with the morphological characteristics of the vitreofoveal adhesion. They propose a preoperative classification of the adhesion based on its shape15:
• V-shaped: the vitreous cortex is detached from the retina both temporally and nasally from the fovea and remains attached only at the fovea. (smaller cross-sectional area and greater tractional force)
• J-shaped or arc shaped: the vitreous cortex is detached from the retina temporally from the fovea, but remains attached to the retina nasally at the fovea itself (larger cross-sectional area and lesser tractional force)
Since stress (σ) can be equated to the force (F) applied per cross-sectional area (A) perpendicular to the force (σ = F/A), it is expected that there will be greater tractional force in eyes with focal attachment, as the angle of the vector is more perpendicular to the retinal surface.
Ultrasound
The importance of ultrasound in imaging the Vitreoretinal interface has steadily decreased with the advent of OCT due to its superior resolution and ease of use. B-scan ultrasound us-

ing 10 and 20 MHz frequencies may be employed to assess partial posterior vitreous detachment, which appears as thin, smooth, and continuous membrane with focal attachment with minimal subsequent anterior movement relative to the retinal surface.
Ultrasound remains useful for investigating whether the posterior hyaloid, that is not visible on OCT, is fully attached or completely detached from the retina and located beyond the scan depth of OCT, unless there is access to a previous OCT examination of the same patient showing partial vitreous detachment.16
The differential diagnosis may include:
• Early full-thickness macular hole
• Pseudophakic CME
• Other causes of CME (uveitis, diabetic macular edema, exudative age-related macular degeneration, macular telangiectasia)
• Epiretinal Membrane
Management
Observation
In 10-11% of cases, VMT can resolve spontaneously without intervention resulting in a posterior vitreous detachment (PVD).17–19 The severity of VMT, defined as the adhesion between the vitreous gel and the macular tissue, is correlated with the likelihood of spontaneous resolution (Figure 5).20 However, resolution is difficult to predict, so observation is currently recommended as the standard of care for at least 3 months before starting any treatment to avoid unnecessary surgery.
Ocriplasmin
The primary event leading to the resolution of the VMT is the occurrence of PVD. It is made possible by the attenuation of the adhesive forces between the cortical vitreous and the internal limiting membrane (ILM). This process is altered when firm vitreoretinal adhesions are present. An alternative to the surgical approach is the controlled induction of vitreous liquefaction associated with accelerated weakening of vitreoretinal adhesions. Many studies have
been conducted on substances targeting the biochemical components of the vitreomacular interface, such as chondroitinase, dispase, and hyaluronidase, but they were abandoned due to insufficient clinical efficacy, complications, or both.21–23
Ocriplasmin is a truncated form of plasmin that has proven effective in ex vivo studies on vitreolysis in animals and humans.24–26 It exhibits proteolytic activity against the molecular substrates responsible for vitreomacular traction, representing a potential nonsurgical, biological approach to treating this disorder. Its activity profile is similar to that of plasmin, targeting both laminin and fibronectin at the vitreoretinal interface. However, due to its significantly smaller size compared to plasmin,ocriplasmin can more easily diffuse through the vitreous gel.27
Better results have been achieved with intravitreal injection of a single 125-μg dose of ocriplasmin or up to three injections of 125-μg each administered monthly. These injections can induce the resolution of vitreomacular traction and the closure of macular holes without causing severe adverse events.28,29 As described by Haller et. Al 30 there are many prognostic factors that can lead to a higher success rate of this procedure: younger patients (<65 years), eyes without epiretinal membrane, eyes with FTMH, phakic eyes, and eyes with a focal VMA ≤ 1500 μm. The extent of VMA has been studied by different groups that have reported better outcomes with a smaller adhesion areas.31,32
Although intravitreal injection of ocriplasmin is a less invasive treatment than vitrectomy, several side effects have been observed:
• lens subluxation or phacodonesis
• dyschromatopsia
• reversible electroretinogram changes
• self-limiting ellipsoid layer OCT changes
• retinal tear or detachment
• endophthalmitis
• persistent reduction of visual acuity. 33
Pneumatic vitreolysis
In 1993, Chan first proposed intravitreal injection of a small quantity of expansile gas (pneumatic vitreolysis) to resolve VMT.34 According to several studies, long-acting gas leads to better outcomes.35–39 The injection is generally preceded by a prophylactic anterior chamber paracentesis to remove 0.1 ml to 0.2 ml of aqueous humor. Subsequently, 0.3 ml of filtered perfluoropropane (C3F8) gas is injected through a short 30-gauge needle through the pars plana into the vitreous cavity. The intraocular pressure is measured, and central retinal artery perfusion is monitored. It may be necessary to prescribe ocular hypotensive medications to normalize the intraocular pressure and ensure adequate central retinal artery perfusion before discharging the patient.40 The resolution of VMT generally develops over a period of 30 days, ranging from 5 days to 9 weeks.36
Some side effects have been observed, including:
• retinal tear or detachment
• full thickness macular hole
• cataract progression
• rise of IOP
• central retinal artery occlusion
• endophthalmitis.
As proposed by Ozdemir et al41 a shorter duration of gas in the vitreous chamber may be pref-
erable to avoid possible complications and limitations on the patient’s daily activities. This can be achieved by using SF6 and instructing patients to move their heads forward and backward, a movement that may induce PVD. The literature on this technique and further studies are needed to define its utility.
The primary goal of any intervention in patients with VMT is to release the residual VMA, facilitating the restoration of normal central retinal architecture. Pars plana vitrectomy (PPV) has seen several advancements with narrow-gauge transconjunctival sutureless vitrectomy (TSV) now being routinely performed. Systems with gauges of 20-, 23-, 25-, and 27-gauge are available, each withrelative advantages and disadvantages. The main surgical goal is to remove the abnormally attached posterior hyaloid face. ILM peeling is commonly performed to remove all associated traction. Gas tamponade is not routinely used unless necessary to address peripheral retinal pathology or to facilitate wound closure. PPV is recommended in case of:
• VMT> 1500 μm
• macular holes> 400 microns or ERM,
• tractional macular edema
• perifoveal VMT.
Tractional macular edema is associated with the shape of the vitreous detachment: temporal PVD results in chronic traction on retinal structures, leading to the formation of TME. Chronic TME increases the risk of macular hole or macular atrophy.
Surgical intervention is associated with a reduction of a patient’s subjective symptoms (metamorphopsias, micropsia, photopsia), improvement in visual acuity, and the decrease in TME and CRT.
Postoperative outcomes are associated with the duration of symptoms. In cases of VMT with ERM, PPV + peeling shows improvement of visual acuity and resolution of the retinal surface folds (RSF). Upon release of mechanical traction, the misalignment of the inner neurosensory layers begins to be restored. Mitamura et al observed a significant correlation between a continuous line representing the junction of the inner and outer photoreceptors and the visual acuity in Stratus OCT in patients after ERM peeling at 3 and 6 months after surgery. They observed significantly better visual acuity when this area was intact. Visual recovery times were associated with restoration of the integrity of the outer retinal layer.
Surgical complications may include:
• cataract progression
• new or residual ERM
• full-thickness macular hole/lamellar macular hole
• persistent macular edema
• persistent subretinal fluid
• macular atrophy
• retinal breaks
• visual field defects
• endophthalmitis.
For postoperative monitoring, it is recommended to use the SD-OCT. The advantages of SDOCT include better axial resolution, higher scan speed, and the possibility to scan the entire macular area at each position using the raster mode. This feature allows physicians to predict the visual outcome for each individual patient and to optimize treatment.
References
1. Girach A, de Smet MD, eds. Diseases of the Vitreo-Macular Interface. Springer Berlin Heidelberg; 2014. doi:10.1007/978-3-64240034-6
2. Meuer SM, Myers CE, Klein BEK, et al. The Epidemiology of Vitreoretinal Interface Abnormalities as Detected by Spectral-Domain Optical Coherence Tomography. Ophthalmology. 2015;122(4):787-795. doi:10.1016/j.ophtha.2014.10.014
3. Flaxel CJ, Adelman RA, Bailey ST, et al. Idiopathic Epiretinal Membrane and Vitreomacular Traction Preferred Practice Pattern®. Ophthalmology. 2020;127(2):P145-P183. doi:10.1016/j.ophtha.2019.09.022
4. Zapata MA, Figueroa MS, Esteban González E, et al. Prevalence of Vitreoretinal Interface Abnormalities on Spectral-Domain OCT in Healthy Participants over 45 Years of Age. Ophthalmol Retina. 2017;1(3):249-254. doi:10.1016/j.oret.2016.11.001
5. Bishop PN. Structural macromolecules and supramolecular organisation of the vitreous gel. Prog Retin Eye Res. 2000; 19(3):323-344. doi:10.1016/S1350-9462(99)00016-6
6. Johnson MW. Posterior Vitreous Detachment: Evolution and Complications of Its Early Stages. Am J Ophthalmol. 2010;149(3):371-382.e1. doi: 10.1016/j.ajo.2009.11.022
7. Di Michele F, Tatone A, Romano MR, Repetto R. A mechanical model of posterior vitreous detachment and generation of vitreoretinal tractions. Biomech Model Mechanobiol. 2020;19(6):2627-2641. doi:10.1007/s10237-020-01360-1
8. Duker JS, Kaiser PK, Binder S, et al. The International Vitreomacular Traction Study Group Classification of Vitreomacular Adhesion, Traction, and Macular Hole. Ophthalmology. 2013;120(12):2611-2619. doi:10.1016/j.ophtha.2013.07.042
9. Steel DHW, Lotery AJ. Idiopathic vitreomacular traction and macular hole: a comprehensive review of pathophysiology, diagnosis, and treatment. Eye. 2013;27(S1):S1-S21. doi:10.1038/eye.2013.212
10. Simpson ARH, Petrarca R, Jackson TL. Vitreomacular Adhesion and Neovascular Age-Related Macular Degeneration. Surv Ophthalmol. 2012;57(6):498-509. doi:10.1016/j.survophthal.2012.01.011
11. Feder RS, Olsen TW, Prum BE, et al. Comprehensive Adult Medical Eye Evaluation Preferred Practice Pattern® Guidelines. Ophthalmology. 2016;123(1):P209-P236. doi:10.1016/j.ophtha.2015.10.047
12. Bottós J, Elizalde J, Arevalo JF, Rodrigues EB, Maia M. Vitreomacular Traction Syndrome. J OPHTHALMIC Vis Res. 7(2):14.
13. Johnson MW. Tractional Cystoid Macular Edema: A Subtle Variant of the Vitreomacular Traction Syndrome. Am J Ophthalmol. 2005;140(2):184.e1-184.e10. doi:10.1016/j.ajo.2005.01.033
14. John VJ, Flynn HW, Smiddy WE, et al. CLINICAL COURSE OF VITREOMACULAR ADHESION MANAGED BY INITIAL OBSERVATION. Retina. 2014;34(3):442-446. doi:10.1097/IAE.0b013e3182a15f8b
15. Sonmez K, Capone A, Trese MT, Williams GA. VITREOMACULAR TRACTION SYNDROME. :8.
16. Krebs I, Glittenberg C, Zeiler F, Binder S. Spectral domain optical coherence tomography for higher precision in the evaluation of vitreoretinal adhesions in exudative age-related macular degeneration. Br J Ophthalmol. 2011;95(10):1415-1418. doi:10.1136/bjo.2010.192385
17. Weinand F, Jung A, Becker R, Pavlovic S. [Spontaneous resolution of vitreomacular traction syndrome]. Ophthalmol Z Dtsch Ophthalmol Ges. 2009;106(1):44-46. doi:10.1007/s00347-008-1767-2
18. Hikichi T, Yoshida A, Trempe CL. Course of vitreomacular traction syndrome. Am J Ophthalmol. 1995;119(1):55-61. doi:10.1016/ s0002-9394(14)73813-9
19. Odrobina D, Michalewska Z, Michalewski J, Dzięgielewski K, Nawrocki J. Long-term evaluation of vitreomacular traction disorder in spectral-domain optical coherence tomography. Retina Phila Pa. 2011;31(2):324-331. doi:10.1097/iae.0b013e3181eef08c
20. Lee EK, Lee SY, Lee JY, Heo JW, Yu HG, Chung H. Anatomical configurations of vitreomacular traction syndrome: influence on clinical course and surgical outcomes. Graefes Arch Clin Exp Ophthalmol Albrecht Von Graefes Arch Klin Exp Ophthalmol. 2019;257(8):1631-1639. doi:10.1007/s00417-019-04352-9
21. Lopez-Lopez F, Rodriguez-Blanco M, Gómez-Ulla F, Marticorena J. Enzymatic vitreolysis. Curr Diabetes Rev. 2009;5(1):57-62. doi:10.2174/157339909787314220
22. Rhéaume MA, Vavvas D. Pharmacologic vitreolysis. Semin Ophthalmol. 2010;25(5-6):295-302. doi:10.3109/08820538.2010.5 18865
23. Pharmacologic vitreolysis - PubMed. Accessed May 16, 2022. https://pubmed.ncbi.nlm.nih.gov/9502274/
24. Gandorfer A, Rohleder M, Sethi C, et al. Posterior vitreous detachment induced by microplasmin. Invest Ophthalmol Vis Sci. 2004;45(2):641-647. doi:10.1167/iovs.03-0930
25. de Smet MD, Valmaggia C, Zarranz-Ventura J, Willekens B. Microplasmin: ex vivo characterization of its activity in porcine vitreous. Invest Ophthalmol Vis Sci. 2009;50(2):814-819. doi:10.1167/iovs.08-2185
26. Verstraeten TC, Chapman C, Hartzer M, Winkler BS, Trese MT, Williams GA. Pharmacologic induction of posterior vitreous detachment in the rabbit. Arch Ophthalmol Chic Ill 1960. 1993;111(6):849-854. doi:10.1001/archopht.1993.01090060139038
27. Chen W, Mo W, Sun K, Huang X, Zhang Y lin, Song H yan. Microplasmin degrades fibronectin and laminin at vitreoretinal interface and outer retina during enzymatic vitrectomy. Curr Eye Res. 2009;34(12):1057-1064. doi:10.3109/02713680903308487
28. Benz MS, Packo KH, Gonzalez V, et al. A placebo-controlled trial of microplasmin intravitreous injection to facilitate posterior vitreous detachment before vitrectomy. Ophthalmology. 2010;117(4):791-797. doi:10.1016/j.ophtha.2009.11.005
29. Stalmans P, Delaey C, de Smet MD, van Dijkman E, Pakola S. Intravitreal injection of microplasmin for treatment of vitreomacular adhesion: results of a prospective, randomized, sham-controlled phase II trial (the MIVI-IIT trial). Retina Phila Pa. 2010;30(7):1122-1127. doi:10.1097/IAE.0b013e3181e0970a
30. Haller JA, Stalmans P, Benz MS, et al. Efficacy of intravitreal ocriplasmin for treatment of vitreomacular adhesion: subgroup analyses from two randomized trials. Ophthalmology. 2015;122(1):117-122. doi:10.1016/j.ophtha.2014.07.045
31. Maier M, Abraham S, Frank C, Lohmann CP, Feucht N. [Pharmaological vitreolysis with ocriplasmin as a treatment option for symptomatic focal vitreomacular traction with or without macular holes (≤400 μm) compared to tranconjunctival vitrectomy]. Ophthalmol Z Dtsch Ophthalmol Ges. 2017;114(2):148-154. doi:10.1007/s00347-016-0322-9
32. Al-Nawaiseh S, Rickmann A, Seuthe AM, Al-Rimawi D, Viktor Stanzel B, Szurman P. REVISED PREDICTIVE BIOMARKER FOR OCRIPLASMIN THERAPY IN VITREOMACULAR TRACTION DISORDERS. Retina Phila Pa. 2021;41(12):2549-2555. doi:10.1097/ IAE.0000000000003244
33. Johnson MW, Fahim AT, Rao RC. Acute ocriplasmin retinopathy. Retina Phila Pa. 2015;35(6):1055-1058. doi:10.1097/ IAE.0000000000000667
34. Chan CK, Wessels IF, Friedrichsen EJ. Treatment of idiopathic macular holes by induced posterior vitreous detachment. Ophthalmology. 1995;102(5):757-767. doi:10.1016/s0161-6420(95)30958-x
35. Claus MG, Feron E, Veckeneer M. Pneumatic release of focal vitreomacular traction. Eye Lond Engl. 2017;31(3):411-416. doi:10.1038/eye.2016.231
36. Chan CK, Crosson JN, Mein CE, Daher N. PNEUMATIC VITREOLYSIS FOR RELIEF OF VITREOMACULAR TRACTION. Retina Phila Pa. 2017;37(10):1820-1831. doi:10.1097/IAE.0000000000001448
37. Day S, Martinez JA, Nixon PA, et al. INTRAVITREAL SULFUR HEXAFLUORIDE INJECTION FOR THE TREATMENT OF VITREOMACULAR TRACTION SYNDROME. Retina Phila Pa. 2016;36(4):733-737. doi:10.1097/IAE.0000000000000760
38. Veith M, Penčák M, Ernest A, Straňák Z. Treatment of Vitreomacular Traction with Intravitreal Injection of Perfluoropropane. Ceska Slov Oftalmol Cas Ceske Oftalmol Spolecnosti Slov Oftalmol Spolecnosti. 2019;75(4):182-187. doi:10.31348/2019/4/2
39. Rodrigues IA, Stangos AN, McHugh DA, Jackson TL. Intravitreal injection of expansile perfluoropropane (c(3)f(8)) for the treatment of vitreomacular traction. Am J Ophthalmol. 2013;155(2):270-276.e2. doi:10.1016/j.ajo.2012.08.018
40. Chan CK, Mein CE, Crosson JN. Pneumatic Vitreolysis for Management of Symptomatic Focal Vitreomacular Traction. J Ophthalmic Vis Res. 2017;12(4):419-423. doi:10.4103/jovr.jovr_146_17
41. Özdemir HB, Özdek Ş, Hasanreisoğlu M. Pneumatic Vitreolysis for the Treatment of Vitreomacular Traction Syndrome. Turk J Ophthalmol. 2019;49(4):201-208. doi:10.4274/tjo.galenos.2019.00400
Teresio Avitabile, Niccolò Castellino, Corrado Pizzo
Introduction
Retinal Detachment (RD) is defined as the loss of adherence of the neurosensory retina from the retinal pigment epithelium (RPE). It’s a dangerous disease because if untreated, it could lead to blindness, especially if the macula (which is engaged in the central vision) is involved[1] We can distinguish three forms of RD: rhegmatogenous (RRD), tractional (TRD) and exudative. Rhegmatogenous Retinal Detachment is the most common form of RD and occurs when the vitreous body passes through a retinal break in the neurosensory retina and separates it from the RPE[2]. Symptoms referred by patients affected by RRD are floaters, flashes, and visual field loss. Floaters are usually related to vitreous filaments moving freely in the vitreous chamber: when they impact with the neurosensory retina, they stimulate flash. It should be kept in mind that the onset of floaters and flash may anticipate RRD and they may represent warning symptoms. Pathogenesis of RRD is based on two essential conditions: liquefaction of the vitreous body and a retinal break, through which fluid gains access into the subretinal space (liquefied vitreous is able to flow through retinal breaks). Posterior vitreous detachment (PVD) plays an important role in RRD: when the posterior hyaloid detaches from the retina (because of syneresis and synchysis related to ocular trauma/surgery, myopia, age), it could also pull out the retina and create a hole or retinal break. PVD increases with age, occurring in 11% of 60-69-year-olds and 46% of 80-89-year-olds. Almost all of the (80-90%) RRD cases are associated with retinal-break formation at the time of PVD. Retinal break is defined as a full-thickness defect in the neurosensory retina. Different retinal sectors do not have equal occurrence of retinal breaks. The most likely location for retinal breaks is the supero-temporal sector, which represents 60% of the overall retinal breaks. In addition, retinal breaks in the supero-temporal sector are associated with the highest incidence of RRD. In contrast, the infero-nasal sector is the least likely location for retinal breaks (10%).
Patients may also complain about blurred vision when a mild hemorrhage associated with the retinal break is present. Patients affected by RRD feel like there is a curtain over their visual field, which does not allow them to focus on their target. Visual acuity ranges from excellent to very poor, depending on whether the macula is still attached (macula on or macula off RRD). This is the reason why RD is an emergency condition and prompt surgical treatment is needed.
Tractional retinal detachment (TRD) is caused by the traction of proliferative membranes over the retina. The proliferative membranes can result from different etiologies of proliferative retinopathies, which lead to vitreoretinal proliferation. RPEs and retinal cells (glial cells, Müller cells), due to inflammatory responses induced by cytokines and growth factors, migrate to the surface of the retina and into the internal limiting membrane (ILM). There, they transform into mesenchymal cells (myofibroblast), which create a cellular matrix and a contractile membrane capable of separating (or tearing) the neuroretina from
the RPE and creating a passage through which the vitreous body enters and causes retinal detachment(3)
TRD can result from different etiologies including Proliferative Diabetic Retinopathy, (PDR)
Retinal vein occlusion (RVO), Retinal Vasculitis, Sickle cell retinopathy, Uveitis, Penetrating trauma, Retinopathy of prematurity (ROP) and Toxoplasma retinitis.
Proliferative Diabetic Retinopathy is the most common cause of TRD. Hyperglycemia-related oxidative stress causes a proinflammatory environment with cytokine upregulation, leukostasis and vessel inflammation. The deterioration of the blood-retinal barrier and retinal ischemia in patients affected by long-term diabetic retinopathy, associated to the over-production of vascular endothelial growth factor (VEGF) and cytokines leads to an abnormal and pathological neo-angiogenesis in the vitreomacular interface. Neovessels grow between the internal limiting membrane and the posterior hyaloid, and eventually invade the posterior cortical vitreous. These new vessels are associated with fibrotic tissue and contractile elements, resulting in anteroposterior and tangential tractions on the retina. The recurrent action of tractional forces causes the deformation and detachment of the neuroretina.
It should be taken into account that PDR represents 5-10% of the overall cases of Diabetic Retinopathy. Monitoring diabetic retinopathy through periodic retina evaluation and fluorescein angiography is necessary to prevent the complications related to PDR, such as retinal detachment and neovascular glaucoma, which lead to blindness.
Exudative retinal detachment is defined as the accumulation of fluid in the subretinal space in absence of retinal breaks or tractions. It can be caused by many retinal and choroidal conditions of inflammatory, infectious, vascular, neoplastic and degenerative nature, capable of breaking down the blood retina barrier with consequent collection of fluid under the neurosensory retina. The inflammatory environment affecting retinal vascularization causes an increase in vascular permeability with transudation of fluid into the extravascular space. No epidemiological data are available for exudative retinal detachment since it is related to multiple diseases[4]. One or both eyes can be involved, the clinical presentation is characterized by the absence of symptoms associated with retinal traction. The “shifting fluid” sign can be detected during a fundus examination with gravitational location of SRF.

Incidence and risk factors
RRD is the pattern of Retinal Detachment which offers the most epidemiological data. The Annual incidence of RRD in Europe is about 10-13 cases per 100,000 individuals. Two age peaks of incidence have been identified and the highest incidence rate is represented by the age range 60-69 because of the high prevalence of posterior vitreous detachment. The second peak occurs in the 20-30 age range, in patients affected by high myopia. Vitreous abnormalities and PVD occur earlier and more frequently in myopic subjects because of the higher axial length. Risk factors for RRD are[5,6]:
– Age: After 60 years of age, the risk of RRD occurrence can be up to twenty times higher in comparison to subjects under 30 years of age. Accordingly, the RRD incidence rate in subjects under 20 years of age was the lowest detected, with less than 3 cases per 100,000 inhabitants.
– Myopia: It represents a major risk factor because of the higher incidence of PVD, vitreous liquefaction and rhegmatogenous peripheral lesion.
–
Ethnicity: Few studies have evaluated the impact of ethnic variation on RRD occurrence. However, the incidence of this pathology is highly influenced by ethnicity, despite the reason being unclear to this date. In Singapore, the incidence of RRD in the Chinese population is three times higher than in Indians, in spite of similar risk factors. A study from the U.K. has detected three times less incidence in Asians in comparison with Caucasians. The higher incidence of RRD in Blacks, compared to Caucasians, has been supported by many studies.
– Season: Seasonal variation in the incidence of RRD has been reported. The effects of high temperature and light on the vitreous has been involved in determining a summer peak and winter trough.
– Peripheral retinal degeneration: The presence of retinal peripheral degeneration such as lattice degeneration, snail track degeneration, retinoschisis and tuft can predispose to retinal break. However, these lesions are very common in the general population and carry a low risk of progression. The risk significantly increases in myopic subjects.
– Pseudophakia: The risk of RRD is increased in subjects who have undergone cataract surgery and it varies according to the surgical method employed. Cataract extraction is associated with a higher rate of PVD and a lower hyaluronic acid concentration, determining vitreous collapse.
– Sex: Male predominance against female has been described In terms of the epidemiology of tractional retinal detachment, little data have been reported because of its multifactorial etiology. However, Poulsen et al reported the incidence of primary tractional retinal detachment in Denmark to be 1.25 per 100,000 inhabitants per year[7]
The main risk factors of tractional retinal detachment are any condition which could lead to vitreoretinal proliferation. Epidemiologically speaking, TRD occurrence can be divided in two main groups: the first affects the adult population and includes Proliferative diabetic retinopathy, Retinal vein occlusion, retinal vasculitis; while the second group is characterized by retinal conditions affecting the pediatric population, such as Retinopathy of prematurity (ROP), Familial exudative vitreoretinopathy, Persistent fetal vasculature, Toxoplasma retinitis and Sickle cell retinopathy. Uveitis, Proliferative vitreoretinopathy (PVR), and penetrating trauma represent causes detectable in both adults and pediatric subjects.
Retinal detachment is an emergency situation: it should be treated as soon as possible. It’s a painless condition and warning signs are: floaters, flashes (photopsia), and reduced/blurred vision (patient may complain that a curtain is affecting his or her sight).
Slit lamp biomicroscopic examination is essential to the evaluation of the entire ocular globe: this instrument provides a magnified view of eye structure thanks to a high intensity light source which is focused on the segment that the examiner wants to evaluate.
If TRD or long-standing chronic RD are suspected, it is important to determine whether iris and angle neovascularization are present.
Intraocular pressure (IOP) assessment is of pivotal importance, often the IOP of the affected eye is 5 mmHg lower than in the fellow eye because of ciliary body dysfunction. In cases of RRD associated with ocular trauma, IOP may be higher than in the fellow eye because of angle recession. Anterior chamber’s Tyndall could be related to inflammatory, pigment or hematic cells. Lens status has to be determined: cataract, pseudophakia, lens dislocation and other conditions play an important role in the choice of treatment. Retina status can be evaluated through indirect ophthalmoscopy: this examination helps to detect the number of retinal breaks, presence of PVR, macula involvement, vitreous status, foreign body, age of detachment, macular hole and other retinal conditions. If the patient presents a trauma with foreign body, Computed Axial Tomography should always be applied to detect it and to analyze the status of the orbit.
Indirect ophthalmoscopy is a difficult procedure with a long learning curve for residents and it is a stressful exam for the patient. Dilation of the pupil by 1% tropicamide or 0,5% phenylephrine administration is required to conduct a proper examination of the peripheral retina. The most common type of retina evaluations are:
– Slit lamp examination with + 90-diopter (D) lens is better for examination of the posterior pole and for a more detailed visualization of the optic nerve and macula. Easier to perform when the pupil doesn’t dilate as much as necessary.
– Binocular indirect ophthalmoscopy with a Schepens helmet and a + 20 D lens, with patient in the supine position. The specialist invites the patient to direct his or her sight in a specific direction for an optimal view of the interested area of the retina. During this exam it is possible to better recognize retinal tears and degeneration through a depression of the eyeball, by using a scleral depressor. Anesthesiologists could make this type of examination more comfortable for the patient.
B-scan echography is of pivotal importance: it helps to analyze structures of different densities. It could provide simultaneous imaging of the macula, optic nerve and peripheral retina. It analyses:
– Posterior lens / IOL (intraocular lens) dislocation
– Foreign body /vitreous opacity and subsequent beam of echo-bright signals and orbital shadow
– Vitreous body synchysis and syneresis (vitreous classically displays a wave-like, undulating aftermovement)
– Vitreous hemorrhage / debris
– Silicon oil droplets
– PVD
–
Vitreous particle’s motion
– Vitreo-retinal traction
– Retinal break




– RD (retina is usually thicker than hyaloid and string-like when detached). Its movement depends on the type, localization, PVR)
– Choroid detachment
– Subretinal hemorrhage
– Choroidal / retinal neoplasia
Optical coherence tomography (OCT) imaging is helpful, even if it studies the macula only. Important surgical parameters that OCT can detect are: the presence of macular hole, subretinal fluid, PVR (it assesses grades and dimension of the membranes), and vitreomacular traction. The identification of the aforementioned parameters is important to plan surgery and to get prognostic information.
Prognosis and treatment criteria
If left untreated, RD leads to blindness. Nowadays, RRD is treated by scleral buckling (SB), pneumoretinopexy or pars plana vitrectomy (PPV). RD cases are usually divided into “macula on” (fovea is still attached to the EPR) and “macula off” (the center is involved). Macula on RD has a better prognosis than macula off RD. The Macula represents the center of the retina,
where the biggest number of photoreceptors can be found, and is involved in central vision: the involvement of the fovea affects the patient’s visual outcome. It should be kept in mind that macula on RD can quickly convert into a macula off detachment, which means that timing the surgery is very important: macular detachment should be treated earlier than 3 days in order to improve final visual acuity.
Macula detachments older than 6 weeks have a poor prognosis and visual recovery is significantly poorer if patients are operated 4 days or later after symptoms begin. The choice of surgical technique depends on the following parameters:
– Age
– Lens status (phakic, pseudophakic and aphakic)
– Ocular opacity
– Number and sites of the retinal lesions
– RD extension
– PVR grade
RRD consequences may be dramatic: 40% of patients won’t be able to read, 10-40% may need more than one surgical procedure and 5% of the eyes have an anatomical or functional failure. Despite surgical progress, functional outcomes remain poor, with only 42% obtaining a visual acuity of 20/40, which drops to 28% if RRD is associated with macular detachment (macula off RD).
Over the last few decades, the way we treat this condition has changed: since the advent of vitrectomy, more surgeons have started using this technique rather than pneumoretinopexy and Scleral buckling. The treatment choice varies according to the above-mentioned clinical factors and the surgeon’s individual preference. Three main groups of RD may be distinguished according to the preoperative retinal condition[8,9]:
– Uncomplicated RRD: it is usually a limited RD, with one or few tears close to each other, limited retinal detachment. The fundus visibility is good. It’s recommended to approach it with SB technique or pneumoretinopexy.





– Complicated RRD: it has a giant tear, vitreous hemorrhage, tears/holes at the posterior pole and/or PVR. PPV with endotamponade is indicated.
– “Gray zone” RRD group: RD with more than one retinal break or unusual retinal breaks with vitreous traction or a RRD in which no retinal break was detected in the preoperative examination or a RRD in a pseudophakic eye. In this group of RD there is poor agreement between surgeons on the preferable surgical techniques.
The surgical approach to TRD is based on vitrectomy and retinal photocoagulation. This pathology represents a frequent indication of the need for vitrectomy in diabetic eyes. TRD can be associated with rhegmatogenous retinal detachment or vitreous hemorrhage. The most important clinical condition in patients affected by TRD is macula involvement, which is associated with severe visual decline and requires prompt PPV. Preoperatory anti-VEGF intravitreal injections can be performed a few days before in order to reduce the risk of intraoperative bleeding.
Exudative retinal detachment is usually not managed surgically, it is important to identify the retinal or systemic condition linked to the retinal exudation and treat it.
Bibliography
1. Pastor JC, Fernández I, Rodríguez de la Rúa E, Coco R, Sanabria-Ruiz Colmenares MR, Sánchez-Chicharro D, et al. Surgical outcomes for primary rhegmatogenous retinal detachments in phakic and pseudophakic patients: the Retina 1 Project--report 2. Br J Ophthalmol [Internet]. 2008 Mar [cited 2021 Aug 5];92(3):378–82. Available from: http://www.ncbi.nlm.nih.gov/ pubmed/18303159.
2. Mitry D, Charteris DG, Fleck BW, Campbell H, Singh J. The epidemiology of rhegmatogenous retinal detachment: Geographical variation and clinical associations. Br J Ophthalmol. 2010;94(6):678–84. .
3. Idrees S, Sridhar J, Kuriyan AE. Proliferative Vitreoretinopathy: A Review. Int Ophthalmol Clin [Internet]. 2019 [cited 2021 Aug 5];59(1):221–40. Available from: http://www.ncbi.nlm.nih.gov/pubmed/30585928.
4. Amer R, Nalcı H, Yalçındağ N. Exudative retinal detachment. Surv Ophthalmol [Internet]. 2017 [cited 2021 Aug 5];62(6):723–69. Available from: http://www.ncbi.nlm.nih.gov/pubmed/28506603.
5. Li JQ, Welchowski T, Schmid M, Holz FG, Finger RP. Incidence of rhegmatogenous retinal detachment in Europe - A systematic review and meta-analysis. Ophthalmologica. 2019;242(2):81–6.
6. Mitry D, Charteris DG, Yorston D, Siddiqui MAR, Campbell H, Murphy A-L, et al. The epidemiology and socioeconomic associations of retinal detachment in Scotland: a two-year prospective population-based study. Invest Ophthalmol Vis Sci [Internet]. 2010 Oct [cited 2021 Aug 5];51(10):4963–8. Available from: http://www.ncbi.nlm.nih.gov/pubmed/20554615.
7. Poulsen CD, Peto T, Grauslund J, Green A. Epidemiologic characteristics of retinal detachment surgery at a specialized unit in Denmark. Acta Ophthalmol. 2016;94(6):548–55.
8. Heimann H, Hellmich M, Bornfeld N, Bartz-Schmidt KU, Hilgers RD, Foerster MH. Scleral buckling versus primary vitrectomy in rhegmatogenous retinal detachment (SPR Study): Design issues and implications SPR Study report no. 1. Graefe’s Arch Clin Exp Ophthalmol. 2001;239(8):567–74.
9. Feltgen N, Weiss C, Wolf S, Ottenberg D, Heimann H, SPR Study Group. Scleral buckling versus primary vitrectomy in rhegmatogenous retinal detachment study (SPR Study): recruitment list evaluation. Study report no. 2. Graefes Arch Clin Exp Ophthalmol [Internet]. 2007 Jun [cited 2021 Aug 5];245(6):803–9. Available from: http://www.ncbi.nlm.nih.gov/pubmed/17120014.
Paolo Carpineto, Agbeanda Aharrh-Gnama, Carla Iafigliola, Luca Cerino, Arturo Licata
The first successful retinal detachment (RD) surgical treatment [1] in literature was described by Gonin in 1920.
Since then, the development of several technologies and increasingly sophisticated techniques allowed RD surgeons to make extraordinary progress and to achieve significantly improved rates of success. However, about 10% of patients today may still require additional surgeries to repair recurrent RDs, and the main cause of surgical failure is represented by the development of proliferative vitreoretinopathy (PVR).
First introduced in 1983 by the Retina Society Terminology Committee, the term PVR [2] refers to an abnormal scarring process that complicates RD and is characterized by the growth of fibrocellular membranes within the vitreous cavity and on both sides of the retinal surface, as well as intraretinal fibrosis [3]. The presence of myofibrils can cause contraction of these epiand subretinal membranes and tractional RDs with fixed retinal folds, mostly due to the contents of collagen in the extracellular matrix.
Despite the evolution of vitreoretinal surgical techniques [4] the incidence of PVR has remained substantially unchanged over the last 25 years. PVR tends to complicate from 5.1% to 11.7% of rhegmatogenous RDs [3]. Recurrent retinal detachment due to PVR mostly appears within the first three months after surgery, with 77% of cases occurring within one month and 95% of cases within 45 days. In the presence of a PVR, RD surgery has an anatomical success rate of 45-85%, while the functional success rate (defined as a final visual acuity of 5/200 or higher) ranges between 26% and 67% [5]
For patients with retinal detachment and PVR there is only a 10 to 40% chance of a successful surgery, regardless of the number of attempts made by the surgeon. Moreover, only 40% to 80% of patients who have achieved anatomic success may obtain the so-called “ambulatory vision”, namely a vision good enough to see large objects at close range [6]
The risk factors for PVR development have been classified as preoperative, intraoperative, and postoperative, as well as behavioral and genetic.
The preoperative risk factors include a large extent of RD, retinal breaks greater than one clock hour, multiple or undetected retinal breaks, vitreous hemorrhage, choroidal detachment, aphakia, previous failed attempts in reattachment, prolonged intraocular inflammation, high myopia, previous retinitis, and traumatic open-globe injuries [8]
The intraoperative risk factors include vitreous or subretinal hemorrhage, excessive cryotherapy or photocoagulation, loss of vitreous and retinal incarceration during sub-retinal fluid (SRF) drainage, and the incomplete sealing of retinal tears.
Postoperative risk factors include uveitis, intraocular hemorrhage after surgery, choroidal detachment, multiple surgical procedures, persistent traction on retinal tears, and air tamponade [5,7,8] .
The main behavioral risk factor identified in PVR development is cigarette smoking after both traumatic [9] and primary retinal detachment [10]
Some variants of inflammatory mediators and cell cycle regulators are considered genetic risk factors. Polymorphisms in TNF and IL1A may be correlated with postoperative PVR [11,12]
Another link has been found between PVR after primary RD repair and a T309G polymorphism in the MDM2 gene [13]. In addition, in a separate case–control study, a p53 gene polymorphism affecting protein function was associated with a greater risk of postoperative PVR in subjects undergoing surgery for primary RD [14]. Furthermore, polymorphisms in the apoptosis mediators BAX and BCL-2 have been identified as predictors of PVR risk [15]
PVR is a multifactorial process whose trigger is the RD itself, since it implies two important phenomena: the blood–retina barrier breakdown and the retinal hypoxia resulting in photoreceptor death. The alteration of the interface between neuroretina and retinal pigment epithelium (RPE) causes the activation of RPE and glial cells that migrate into the vitreous cavity and onto the retinal surface [6,16]
RPE cell transdifferentiation plays a critical role in several retinal diseases, including hereditary retinal dystrophies and age-related macular degeneration, and it represents a key event in the pathogenesis of PVR [17]. RPE consists of a single layer of highly polarized cells lying between photoreceptors and choriocapillaris, with an approximate density of 3.5 × 106 cells in the adult human eye. The proper functioning of RPE requires a specific polarized distribution of transmembrane proteins. For example, Na+/K+-ATPase, intracellular chloride channel, mannose receptors, and monocarboxylic transporter (MCT)1 are confined to the apical portion of RPE cells, while integrins, MCT3, and Bestrophin-1 are located on the basal membrane. In addition, RPE cells also secrete proteins in a polarized manner [18–20]. The vascular endothelial growth factor (VEGF) is secreted primarily in the basal direction to promote the growth of the vascular choroidal system, while the pigment epithelium-derived factor (PEDF), an angiogenic inhibitor, is secreted apically [21,22]
During embryogenesis, the cells’ ability to switch between the epithelial and the mesenchymal statuses is crucial for the development of the human body [21]. These processes are known as Epithelial/Mesenchymal Transition (EMT) and Mesenchymal/Epithelial transition (MET). In healthy tissues, fully differentiated epithelial cells typically perform specific functions and they are not able to transdifferentiate. However, EMT can be activated in pathological circumstances, such as inflammation, wound healing, and carcinogenesis, allowing epithelial cells to achieve a greater migration capacity and to increase their production of extracellular matrix components [23]
Historically, EMT is classified into three subtypes: type I EMT occurs in the early stages of embryogenesis; type II EMT is associated with tissue regeneration and organ fibrosis; type III occurs in cancerous cells and is responsible for invasion and metastasis [24]
The loss of epithelial markers, including zona-occludens-1 (ZO-1), E-cadherin, cytokeratin, and the gain of mesenchymal markers that includes vimentin, N-cadherin, and fibronectin, is typically used to identify EMT. Recently, CD44 and the transmembrane protein Podoplanin have been indicated as potential key actors in EMT [25]
However, the definition of EMT remains strongly debated as it is considered over simplified. In fact, the gain of the ability to invade and migrate is not necessarily accompanied by the com-
plete loss of epithelial traits. It has been proposed that EMT and MET represent the extremes of a continuum, with the existence of intermediate phenotypes.
Adult RPE cells retain the ability to move along a continuum between polarized epithelial cells and mesenchymal cells. The concept of epithelial dysfunction has recently been proposed to define the transition from fully differentiated epithelial cells to mesenchymal cells (including intermediate statuses) [26] .
Multiple inflammatory cells and mediators have been identified in the vitreous humor and within the epiretinal membranes of eyes with PVR, including macrophages, CD4+ and CD8+ Tlymphocytes, and B-lymphocytes, as well as immunoglobulin deposits and complement molecules. Several pieces of laboratory evidence have revealed their essential role in the pathological changes that lead to PVR. Inflammatory cells release cytokines and mitogen factors that stimulate RPE and glial cells to transdifferentiate, proliferate, and deposit fibrous tissue, resulting in epiretinal and subretinal membrane formation [27–31]. The most important factors involved in this process are the platelet-derived growth factor (PDGF), the hepatocyte growth factor (HGF), the VEGF, the Epidermal Growth Factor (EGF), the granulocyte colony stimulating factor (G-CSF), the fibroblast growth factors a and b (aFGF and bFGF), the insulin- like growth factor 1 (IGF1), the transforming growth factors α and β (TGF-α and TGF-β), the tumor necrosis factor α (TNF-α), the in-terferons β and γ (IFN-β and INFγ), the interleukins 1, 1β, 6, 8, and 11 (IL-1, IL-1β, IL-6, IL-8 ,and IL-11), and chemokines, such as the ligand of the chemokines CC 3, 4, and 5 (CCL3, CCL4, and CCL5) [31–46]. Growth factors, cytokines, and chemokines may be potential biomarkers for predicting the development and severity of PVR.
Another key point in understanding PVR pathogenesis is the dysregulation and remodeling of the extracellular matrix (ECM) microenvironment. ECM composition in PVR preretinal membranes has been the subject of immunohistochemistry studies. Morino et al. [47] demonstrated the consistent presence of interstitial collagen of types I and III and the inconsistent presence of type II collagen. Non-collagenous extracellular components of preretinal membranes include glycoproteins (laminin, fibronectin, and tenascin) among whom fibronectin has pivotal importance for cellular adhesion. Fibronectin matrix assembly seems to represent an early step in pathologic ECM protein accumulation. Both plasma- and cell-derived fibronectin can be found in PVR; the first appears as a result of vascular leakage; the second is directly produced by local cells [48]. Fibronectins promote cell–cell and cell– substrate adhesion and are responsible for providing early structural integrity in preretinal membranes and for the formation of a “contractile unit” [49] .
The balance between ECM production and degradation is tightly regulated, and matrix metalloproteinases (MMPs) play an important role in this context [50]. In PVR, ECM synthesis, secretion, and degeneration are stimulated not only by MMPs but also by growth factors, especially TGF-β1 [51]
PVR-derived RPE cells show an altered integrin expression profile if compared to quiescent RPE cells [52] and are likely to be better equipped to engage with fibronectin protein and thus to initiate fibronectin matrix assembly, leading to ECM accumulation [53]. A key role in the pathogenesis of PVR is played by TGF-β2, a pro-fibrotic growth factor known to be elevated in the vitreous of eyes with PVR [54]. RPE cells treated with a transforming growth factor (TGF)-β2 are induced to express fibronectin containing extra domain A (FN-EDA), and this effect is further amplified by co-treatment with a connective tissue growth factor (CTGF) [55] .
Proliferation, migration, and shape change require the partial detachment of cells from their substrate. ECM in wounds contains anti-adhesive proteins, often belonging to a group of proteins known as “matricellular” proteins, which may facilitate cell detachment and hence permit cell proliferation and migration. Matricellular proteins include tenascin, thrombospondin
1 and 2 (TSP1 and TSP2), Secreted Protein Acidic and Rich in Cysteine (SPARC), and osteopontin. Tenascin, TSP1, and SPARC have been described in PVR membranes, and an association between TSP1 and RPE cells, as well as between SPARC and RPE cells, has been observed in these membranes [56]
The levels of both signal transduction proteins and early apoptosis proteins were recently studied in SRF, collected by evacuative drainage during episcleral surgery for macula-off RRDs. The study showed that these proteins are associated with different clinical features and post-surgical outcomes. A lower concentration of caspase-9 was found in the SRF of eyes that developed PVR within 6 months postoperatively, suggesting a protective role of apoptosis activation against the development of PVR. Reduced levels of pro-apoptotic proteins in retinal cells could lead to other forms of cell death, which would increase intraocular inflammation after RRD. The increase in inflammation could generate a cascade of tissue responses that generate and amplify the hostile microenvironment, where the activated RPE cells can migrate and transdifferentiate, resulting in PVR development. Another interesting finding was that the concentration of the p53 protein increased in the SRF of eyes that did not show photoreceptor damage on Optical Coherence Tomography examination. Once activated, following cellular stress, p53 induces a cell cycle arrest to allow for either repair and survival or apoptosis. This indicates that the stress following RD could induce an increase in the concentration of p53, which appears to be protective for photoreceptors, until surgery is performed. Finally, it was demonstrated that higher subretinal ERK1/2 protein concentrations are related to better visual acuities 6 months after surgery, suggesting the functional importance of this protein [57] .
TGF-β is a multifunctional cytokine that regulates the differentiation, migration, apoptosis, and function of the immune cells as well as the synthesis of the extracellular matrix [58,59] High TGF-β concentrations were found in the vitreous humors of eyes with PVR, and they were directly proportional to the extent of fibrosis. TGF-β binds to its receptors to activate multiple downstream pathways, including the Smad-dependent pathway that regulates the expression of target genes, inducing an increased expression of mesenchymal markers like alpha-actin of smooth muscle (α-SMA) and vimentin and reduced expression of epithelial markers, such as the ZO-1 [60–62]. Tissue fibrosis and contraction are critically dependent on the TGF-β/Smad pathway. Therefore, blocking the Smad signal effectively suppresses fibrogenesis reactions inhibiting EMT as well as the conversion from fibroblasts to myofibroblasts [63,64]
In eyes with PVR, a high expression of PDGF and its receptor in both the RPE cells and Muller cells was found. It was shown that the PDGF α receptor (PDGFR-α) is activated in PVR-affected eyes [65]. Other molecules such as VEGF, FGF, EGF, insulin, and HGF can indirectly activate PDGFR-α, promoting the persistence of the signaling responsible for cell survival, proliferation, and contraction involved in the development of PVR [66,67]
Another growth factor implicated in the development of PVR is the profibrotic TNF-α. It was shown that polymorphisms of profibrotic genes alone are not predisposed to the development of PVR, but if associated with the polymorphisms of the genes involved in apoptosis, they significantly increase the risk of PVR formation. This supports the theory that both processes play a key pathophysiological role in the development of PVR [68,69]
Cell death pathways can influence the development of intraretinal fibrosis. While some authors support the protective role of apoptosis [57], others consider it is a mechanism involved in the development of PVR [70–72]. Apoptosis has two main signaling cascades that lead to DNA fragmentation and cell death, which are both mediated by caspase [73–76]
Photoreceptor death induces the release of cytokines, which can attract and activate macrophages, Muller cells, astrocytes, and microglia. The activation of these cells leads to oxida-
tive stress, which could further contribute to the cytotoxic effect on photoreceptors triggered by retinal detachment [77]
In addition to RPE cells, inflammatory cells and glial cells are also an active component of PVR [78]. The loss of neurons stimulates the hypertrophy of retinal glial cells (mainly Muller cells, but also astrocytes and microglia) responsible for retinal remodeling. These intraretinal changes can cause retinal stiffening and shortening, a phenomenon defined as intraretinal PVR. Changes in Muller cells start twenty-four hours after retinal detachment onset, and within three days, their cell bodies migrate toward the outer nuclear and outer plexiform layers, occupying the spaces left by dying photoreceptors with the extension of their processes in the subretinal space. Muller cells constitute only 20% of the retinal volume, and their hypertrophy cannot counteract the important loss of neurons induced by retinal detachment, resulting in a shortening of the retina [79–82]
In recent years, PVR physiopathology knowledge has enhanced thanks to studies regarding the role of non-coding RNAs. Different microRNAs (miRNAs) have been related both to RRD clinical features linked to progression toward PVR [83] and to PVR it-self [84]. A positive association has been found between the expression of miR-21 and miR-34 and the duration of symptoms related to retinal detachment [83]. The expression of miR-143-3p, miR-224-5p, miR-361-5p, miR-452-5p, miR-486-3p, and miR891a-5p increased with the worsening of PVR grading [84]
In 1983, the Retina Society Terminology Committee introduced the first PVR classification, including four degrees of severity [2]:
• Grade A or minimal PVR: vitreous haze, vitreous pigment clumps, and/or pigment clusters on inferior retina.
• Grade B or moderate PVR: wrinkling of inner retinal surface, retinal stiffness, vessels tortuosity, and/or rolled edges of the retinal breaks.
• Grade C or marked PVR: full thickness retinal folds in 1 (C-1), 2 (C-2), or 3 (C-3) quadrants.
• Grade D or massive PVR: fixed retinal folds in four quadrants with a wide (D-1), narrow (D-2), or closed funnel retinal detachment configuration, without visualization of the optic disc (D-3). This classification has proven to have poor clinical value since the four grades provide an incomplete report of the disease severity due to the absence of differentiation between anterior and posterior, as well as preretinal and subretinal PVR.
Grade C-P: Full-thickness retinal folds and/or subretinal strands posterior to the equator (12–1 clock hours involvement)
Type 1
Type 2
Type 3
Focal contractions with formation of star folds.
Diffuse contraction resulting from confluent star folds (optic disc may not be visible).
Subretinal proliferation with annular or linear strands.
Grade C-A: Full-thickness retinal folds and/or subretinal strands anterior to the equator (12–1 clock hours involvement), and anterior displacement.
Type 1
Type 2
Circumferential contraction with inward traction of the retina at the posterior edge of the vitreous base.
Anterior contraction on the retina at the vitreous base with ciliary body detachment and iris retraction.
Table 1. C-posterior and C-anterior grades as modified by 1991 Retina Society PVR classification.
Therefore, in 1989, the Silicone Study Group modified the PVR classification, deleting grade D and replacing grade C with grades C-P (posterior form) and C-A (anterior form), both further subdivided according to the type of contraction and the extent of PVR expressed in clock hours [85,86]
The latest update of the PVR classification was proposed in 1991 by the Retina Society. It improved the previous scheme retaining grades A and B unchanged and modifying grades C-P and C-A with the introduction of five types to obtain a more detailed description of the location of the proliferation and the type of contraction [87]:
• Grade C-P: Full-thickness retinal folds and/or subretinal strands (Figure 3) posterior to the equator (1–12 clock hours involvement) .
Type 1: Focal contractions with formation of star folds.
Type 2: Diffuse contraction resulting from confluent star folds (optic disc may not be visible).
Type 3: Subretinal proliferation with annular or linear strands.
• Grade C-A: Full-thickness retinal folds and/or subretinal strands anterior to the equator (1–12 clock hours involvement), and anterior displacement.
Type 1: Circumferential contraction with inward traction of the retina at the posterior edge of the vitreous base.
Type 2: Anterior contraction on the retina at the vitreous base with ciliary body detachment and iris retraction.
A new classification should certainly consider the stage of the disease, active or quiescent, and the epiretinal, intraretinal, subretinal (shown in Figure 1), or mixed localization of PVR rather than its extent. Intraretinal changes have an enormous influence on surgical complexity and on the anatomical and functional outcomes, especially when the posterior pole is involved, but unfortunately, their clinical relevance can generally only be identified during surgery.
PVR accounted for 75% of surgeries for recurrent retinal detachment [88]. To date, there is no medical therapy that has been approved for the treatment or prevention of PVR. Many pharmacological approaches have proven promising in animal model experiments, including anti-inflammatory, antiproliferative, antineoplastic, antioxidant, and antiangiogenic drugs, but none of them have passed human clinical trials [89]
Corticosteroids (CCS) were the first drugs tested for PVR treatment. Intravitreal triamcinolone acetonide showed some effectiveness in experimental animal models, but human studies revealed poor responses [90–92]. The addition of heparin and dexamethasone (DEX) to the infusion fluid during vitrectomy for PVR increased the rate of postoperative bleeding without any improvement in the visual outcome [93]. In a randomized prospective study including a large sample of 140 eyes affected by RRD and treated with vitrectomy, silicone oil tamponade, and intravitreal DEX implant, Banerjee et al. [94] did not observe any benefits compared with a control group in a six-month follow-up, neither in the RD recurrence rate after silicone oil removal nor in terms of visual acuity or quality of life. However, the authors reported a lower rate of postoperative macular edema in the DEX implant group than in the control group (42.7% versus 67.2%). An excessive anti-inflammatory activity that prevents retinal remodeling after RD repair could explain the poor postoperative visual outcomes in the DEX group despite the lower rate of postoperative macular edema.
Postoperative CCS therapy to prevent PVR has also been investigated. It was hypothesized that systemic CCS could reduce postoperative inflammation and counteract the increased levels of inflammatory cytokines responsible for the development of post-operative PVR. Two
randomized prospective studies investigated the effectiveness of postoperative CCS and reported controversial results. Dehghan et al. [95] observed neither visual or anatomical improvement nor a reduction in postoperative complications (cystoid macular edema and PVR) using oral prednisolone 1 mg/kg/day for 10 days after surgery. Conversely, Koerner et al. [96] showed that oral prednisone at the starting dose of 100 mg/day for six days, tapered to 50 mg/day for five days, and 12.5 mg/day for four days, was effective in reducing the incidence of postoperative complications such as Grade B PVR (26.7%, 23.6%, and 19.8% in the steroid group and 41.8%, 46.9%, and 39.1% in the placebo group at one, three, and six months after surgery, respectively).
Antiproliferative and antineoplastic agents that have been studied for the prevention and treatment of PVR include 5-fluorouracil (5-FU), retinoic acid, daunorubicin, taxol, colchicine, ribozymes, vincristine, cisplatin, adriamycin, and mitomycin. 5-FU is an antimetabolite drug that inhibits the fibroblast’s proliferation and function, and it is one of the most tested drugs for PVR treatment. A large, randomized trial tested the efficacy of a combined therapy with 5- FU and low-molecular-weight heparin in RRDs with PVR, and it did not reveal any improvement in the anatomic and visual outcomes [97]. The addition of 5-FU and low-molecular-weight heparin to the infusion liquid for vitrectomy in eyes with RD relapse and PVR Grade C was recently proposed, showing significantly favorable results [98,99]
Another widely studied drug is daunorubicin (DNR), belonging to the anthracycline family, which was effective in arresting in vitro RPE cell proliferation and migration from eyes with PVR [100]. Preclinical in vivo studies on a PVR model induced by intravitreal macrophage injection showed DNR’s effectiveness in reducing the formation of PVR if injected into the vitreous cavity simultaneously with cells that are able to induce experimental PVR [101]. The study group on daunorubicin demonstrated the existence of benefits from supplementary treatment with DNR during vitrectomy in eyes with idio-pathic PVR, with a significant reduction in the number of reoperations, although the rate of anatomical success after 6 months did not prove significant [102]. In recent years, several studies have tried to obtain a prolonged DNR half-life in the vitreous cavity using liposomes of porous silicon and observed the permanence of DNR therapeutic concentrations in the vitreous cavity for at least three months [103,104]
Another studied therapeutic approach is the creation of a chimeric DNA-RNA ribozyme directed against the mRNA of a cell cycle regulator protein called the Proliferating Cell Nuclear Antigen (PCNA). The hypothesis was that inhibiting PCNA, which is essential in DNA replication, would decrease the proliferation of cells involved in PVR formation after surgical procedures. The ability of the intravitreal injection of this ribozyme to prevent PVR development was tested in a rabbit PVR model with promising results in preclinical studies but failed to show anatomical and functional benefits in multicenter clinical studies [105,106]
Anti-VEGF agents were shown to be effective in inhibiting PVR formation in experimental models [107]. In a prospective randomized study of patients with PVR Grade C who underwent vitrectomy, an intravitreal injection of bevacizumab at the end of surgery resulted in better visual acuities and lower rates of PVR recurrence compared to the control group at seven months after surgery. Similar results were seen in patients with Grade B PVR [108,109] . Retinoic acid promotes the arrest of RPE cell growth in vitro. A small, randomized prospective study assessed the efficacy of oral retinoic acid in patients with PVR Grade C who underwent vitrectomy and showed a significant reduction in RD recurrence rates and an improvement in visual functions [110]. Orally administered isotretinoin (13-cis-retinoic acid) seems to be able to minimize the formation of PVR after retinal reattachment surgery, whereas there was no improvement in the success rate in established PVR [111] Methotrexate (MTX) is a folic acid antagonist that is able to inhibit DNA/RNA synthesis in rap-
idly dividing cells through the blockade of dihydrofolate reductase. At low doses, MTX blocks both cell proliferation and inflammatory pathways by increasing the release of extracellular adenosine, which inhibits macrophage activation, leukocyte recruitment, and neutrophil adhesion [112]. Research about the effects of MTX on preventing or treating PVR is still debated, and the data are not resolutive. A retrospective study evaluating patients with PVR and recurrent retinal tractional detachment revealed a lower PVR incidence in patients treated with intravitreal infusion of methotrexate during vitrectomy [113]. A single intravitreal injection of MTX seemed inadequate to inhibit PVR; its prolonged proliferative cellular response must be suppressed for at least 60-90 days after primary RD. In a recent study, a series of low-dose intravitreal injections of MTX (100–200 µg/0.05 mL) for 4-5 weeks proved effective for the treatment of relapsing RDs caused by severe PVR [114]. Treatment with MTX also suppressed the inflammation that is normally associated with silicone oil tamponade [115]. In a comparative interventional non-randomized study, El Baha et al. [116] compared PPV and MTX adjuvant intravitreal infusion (equivalent to a single 400 µg/0.1 mL dose) versus PPV alone in 190 eyes, subdi-vided into three categories (no risk of PVR, high risk of PVR, and established PVR). They concluded that the usage of MTX gave superior functional outcomes in patients with no risk and patients at high risk of PVR but not in the established PVR group. The authors also reported that PPV and MTX do not seem to confer additional advantages in terms of the retinal reattachment rate if compared to PPV alone. Ullah A et al. [117] evaluated the usage of intravitreal low-dose MTX (200 µg/0.05 mL) during PVR surgery and every two weeks thereafter (mean: 5, 6 doses). They found that the outcomes in terms of the retinal reattachment rate and visual acuity were comparable to those of other reports that used higher doses (400 µg/0.1 mL) with a lower incidence of corneal toxicity (4% vs. 10-42%). The study reported that MTX may also reduce the incidence of post-surgical hypotony in patients with PVR.
Other agents that have proven effective in preventing or treating experimental PVR models in vitro and in vivo by intervening in different phases of PVR pathogenesis are as follows:
• Taxol and colchicine stabilize and inhibit the formation of microtubules. They could reduce RPE migration and proliferation [118]
• Glucosamine is an aminomonosaccharide that suppresses RPE proliferation in vitro, interfering with the TGF-β signaling pathway [119] .
• Hypericin and herbimycin A were effective in preclinical studies by reducing PVR development in animal models of RD [120,121]
• Alkylphosphocholine is a protein kinase C inhibitor that was shown to be effective against RPE migration and proliferation in vitro [122]
• AG1295, a specific PDGFR inhibitor, attenuated PVR development without significant side effects in rabbits [123]
• N-acetylcysteine is an antioxidant agent that showed efficacy in protecting rabbits from PVR formation by blocking the activation of PDGFR-α [124]
• Epigallocatechin gallate, resveratrol, and curcumin are polyphenols tested in vitro for their effect on RPE proliferation. Resveratrol was found to be the most effective by suppressing the Smad pathway in TGF-β2-treated ARPE-19 cells [125,126] .
• Rho-kinase inhibitors can mitigate some of the changes triggered by RD, such as the destruction of the synaptic architecture, the apoptosis of photoreceptors, and the initiation of the EMT that characterizes PVR, promoting retinal cell survival and attenuating glial reactivity [127–129]
• Palomid 529 is an inhibitor of the Akt/mTOR pathways that regulate cell signaling, and in an experimental model of RD in rabbits, it was effective in suppressing Muller cell proliferation, glial scar formation, and photoreceptors death [130]
• Heavy chain hyaluronic acid/pentraxin 3 (HC-HA/PTX3), purified from human amniotic membrane, exerts anti-inflammatory and anti-scarring activities, and it was able to inhibit these PVR-related processes in vitro [131,132] .
• Melatonin inhibited the proliferation and migration induced by EGF in human AR-PE-19 cells by suppressing the AKT/mTOR-mediated Sp1/c-Jun signaling pathways [133]
• IL-10 and antibodies to TGF-beta2 and PDGF have been hypothesized to be therapeutic options since they can inhibit RPE-mediated retinal contraction [134]
Despite their positive results in preclinical models, most of these agents failed to show efficacy in human clinical trials. This may be due to inadequate PVR animal models and an incomplete understanding of its physiopathology. In addition, many patients who were treated with antiproliferative agents showed several side effects. The risks could be balanced by a clear advantage for a patient with a high risk of developing PVR.
Many of the failures of the already-mentioned trials depend on both the difficulty in identifying the range of efficacy and safety of such drugs and the need to maintain adequate therapeutic concentrations until the blood-retina breakdown has been fully repaired. The ideal therapy should therefore include slow-release devices that ensure adequate levels of the drug for the time necessary after surgery. It would also be useful to definitively identify the biomarkers that can point out the cessation of proliferative processes.
In addition to the surgical reattachment of the retina, as a common goal in every case of retinal detachment, the presence of PVR, especially in its higher grades, requires the surgeon to perform further maneuvers, in order to solve the tractions generated by the epiretinal and subretinal membranes, or to counteract the retinal shortening due to intraretinal fibrosis [5]
The first controversy concerns surgical timing. In the presence of an active PVR, some authors prefer to delay the intervention by a few weeks; waiting for the PVR proliferations to completely develop, which allows an easier membrane peeling and therefore ensures a more complete removal of the membranes [135]. Obviously, any decision to delay surgery must be balanced with the macula status and its implications for the visual prognosis.
Another controversial topic concerns the right surgical choice for phakic eyes suffering from high-grade PVR. The chance to perform phaco-vitrectomy should be considered to obtain a complete removal of the anterior vitreous and of the membranes.
The advent of smaller-gauge transconjunctival pars plana vitrectomy (PPV) techniques and the technological advancement of surgical instruments have undoubtedly reduced postoperative inflammation, a well-known risk factor for the development of PVR [135]
The first step is the complete removal of the posterior vitreous, followed by a scleral depression-assisted vitreous base shaving. Triamcinolone acetonide staining is useful for the optimal detection of posterior hyaloid during a posterior vitreous detachment (PVD) induction as well as to better visualize the peripheral vitreous [5]
The peeling of PVR epiretinal membranes (ERMs) is another crucial phase to obtain anatomical success [136]. Vital dyes, such as trypan blue and brilliant blue, highlight both preretinal membranes and the internal limiting membrane (ILM), making their removal easier. Some studies have shown that posterior pole ILM peeling reduces the risk of ERM recurrence and retinal re-detachment [137–140]. More research is needed to gather further evidence on the benefits of posterior ILM peeling in the absence of PVR.
Equally significant was the introduction of chandeliers for endoillumination, enabling the execution of bimanual methods for membrane dissection and peeling in advanced PVR situations [141]


Subretinal PVR bands are often a challenge for the surgeon due to their difficult accessibility and their tractional effect, which rarely precludes retinal reattachment. The removal of subretinal bands can be performed through a small retinotomy or directly under the retina if a large retinectomy is necessary [5]
Intraoperative retinal flattening by perfluorocarbons, the so-called “third hand”, is greatly useful in counteracting the tractional forces generated by membrane peeling. Despite a complete removal of all the membranes, sometimes the retina cannot be completely reattached, due to a high level of intraretinal stiffness. Such cases can be approached through relaxing retinal incisions (retinotomy) or a partial retinectomy, paying attention to a perfect hemostasis at the edges of the incisions to avoid further inflammation from bleeding. Selecting the appropriate tamponade agent is crucial. A multicenter randomized clinical trial compared long-acting gas with silicon oil (SiO) for the surgical management of PVR with vitrectomy, searching for differences in terms of postoperative visual acuity, retinal detachment recurrence rate, and incidence of complications. SiO and perfluoro-propane (C3F8) were found to be equivalent concerning the rate of anatomical success and visual outcomes. Additionally, the study showed that both SiO and C3F8 were superior to sulfur hexafluoride (SF6) in terms of visual outcomes [142] . In PVR, scleral buckling (SB) plays a role in decreasing antero-posterior tractions and supporting the vitreous base, but the anatomic success rate with primary SB surgery for severe PVR retinal detachments ranges from 34 to 47% [135]. Storey et al. [143] compared pars plana vitrectomy (PPV) alone versus PPV and SB in patients deemed at high risk for PVR development. The study identified the patients as at high risk for PVR considering some clinical features: RD in two or more quadrants, retinal tears > 1 clock hour, pre-operative PVR, or vitreous hemorrhage. Better anatomical results were obtained in the second group, but no significant difference between the two groups was found in terms of post-operative visual acuity. In younger patients, a higher rate of PVR was found after PPV for primary RRD; the SB procedure might be advisable as the initial surgical step in patients below 35 years of age [144]
Recently, Caporossi et al. [145] evaluated the efficacy of a modified vitrectomy procedure involving the coverage of exposed RPE in retinal breaks and retinotomy with human amniotic membrane (hAM) patches to prevent postoperative PVR in a series of 15 cases of retinal detachment complicated by severe preoperatory PVR, assuming that hAM can suppress the TGF-β pathway in a selected population of cells involved in the pathogenesis of PVR, including fibroblasts, macrophages, and particularly RPE cells. However, despite the improvement in surgical strategies, PVR still remains one of the most complex challenges in vitreoretinal surgery, both due to the technical difficulties and the unpredictability of the results.
In recent decades, the knowledge of PVR’s physiopathology has improved thanks to biomolecular, genetic, and clinical studies. In addition, the enhancement of technology has allowed less invasive surgical approaches, contributing to an overall reduction of postoperative inflammation. However, a significant percentage of eyes affected by retinal detachment still develop the highest grade of PVR, resulting in very poor functional and anatomic prognosis. To date, clinical studies have not yet clarified the real significance of each single risk factor. For the surgeon, knowing the individual patients’ susceptibilities is key to appropriately managing and treating PVR . Therefore, knowledge is the first step in PVR prevention and high-risk patients through not only clinical but also biological predisposing factors should be identified.
In this perspective, epigenetics with non-coding RNAs has gained increasing interest in the pathophysiology of many eye diseases. MiRNAs play a central role in PVR physiopathology [83,84], and there are promising possibilities to use them as disease biomarkers and master regulators for therapeutic strategies to stabilize or reset the cellular state of neurons and glial cells [146]
References
1. Gloor, B.P.; Marmor, M.F. Controversy over the etiology and therapy of retinal detachment: The struggles of Jules Gonin. Surv. Ophthalmol. 2013, 58, 184–195.
2. The Retina Society Terminology Committee. The classification of retinal detachment with proliferative vitreoretinopathy. Ophthalmology 1983, 90, 121–125.
3. Kwon, O.W.; Song, J.H.; Roh, M.I. Retinal Detachment and Proliferative Vitreoretinopathy. Dev. Ophthalmol. 2016, 55, 154–162.
4. Charteris, D.G.; Sethi, C.S.; Lewis, G.P.; Fisher, S.K. Proliferative vitreoretinopathy-developments in adjunctive treatment and retinal pathology. Eye 2002, 16, 369–374.
5. Idrees, S.; Sridhar, J.; Kuriyan, A.E. Proliferative Vitreoretinopathy: A Review. Int. Ophthalmol. Clin. 2019, 59, 221–240.
6. Pastor, J.C.; de la Rúa, E.R.; Martín, F. Proliferative vitreoretinopathy: Risk factors and pathobiology. Prog. Retin. Eye Res. 2002, 21, 127–144.
7. Sadaka, A.; Giuliari, G.P. Proliferative vitreoretinopathy: Current and emerging treatments. Clin. Ophthalmol. 2012, 6, 1325–1333.
8. Girard, P.; Mimoun, G.; Karpouzas, I.; Montefiore, G. Clinical risk factors for proliferative vitreoretinopathy after retinal detachment surgery. Retina 1994, 14, 417–424.
9. Eliott, D.; Stryjewski, T.P.; Andreoli, M.T.; Andreoli, C.M. Smoking is a risk factor for proliferative vitreoretinopathy after traumatic retinal detachment. Retina 2017, 37, 1229–1235.
10. Xu, K.; Chin, E.K.; Bennett, S.R.; et al. Predictive Factors for Proliferative Vitreoretinopathy Formation after Uncomplicated Primary Retinal De-tachment Repair. Retina 2019, 39, 1488–1495.
11. Rojas, J.; Fernandez, I.; Pastor, J.C.; et al. A strong genetic association between the tumor necrosis factor locus and proliferative vitreoretinopathy: The retina 4 project. Ophthalmology 2010, 117, 2417–2423.e2.
12. Lumi, X.; Jelen, M.M.; Jevšinek Skok, D.; et al. Comparison of SNP Gen-otypes Related to Proliferative Vitreoretinopathy (PVR) across Slovenian and European Subpopulations. J. Ophthalmol. 2018, 2018, 8761625.
13. Pastor-Idoate, S.; Rodríguez-Hernández, I.; Rojas, J.; et al. The T309G MDM2 gene polymorphism is a novel risk factor for proliferative vitreoretinopathy. PLoS ONE 2013, 8, e82283.
14. Pastor-Idoate, S.; Rodriguez-Hernández, I.; Rojas, J.; Fernández, I.; et al. The p53 codon 72 polymorphism (rs1042522) is associated with proliferative vitreoretinopathy: The Retina 4 Project. Ophthalmology 2013, 120, 623–628.
15. Pastor-Idoate, S.; Rodríguez-Hernández, I.; Rojas, J.; Fernández, I.; et al. BAX and BCL-2 polymorphisms, as predictors of proliferative vitreoretinopathy development in patients suffering retinal detachment: The Retina 4 project. Acta Ophthalmol. 2015, 93, e541–e549.
16. Pastor, J.C. Proliferative vitreoretinopathy: An overview. Surv. Ophthalmol. 1998, 43, 3–18.
17. Lee, S.C.; Kwon, O.W.; Seong, G.J.;et al. Epitheliomesenchymal transdifferentiation of cultured RPE cells. Ophthalmic Res. 2001, 33, 80–86.
18. Deora, A.A.; Philp, N.; Hu, J.; Bok, D.; Rodriguez-Boulan, E. Mechanisms regulating tissue-specific polarity of monocarboxylate transporters and their chaperone CD147 in kidney and retinal epithelia. Proc. Natl. Acad. Sci. USA 2005, 102, 16245–16250.
19. Wimmers, S.; Karl, M.O.; Strauss, O. Ion channels in the RPE. Prog. Retin. Eye Res. 2007, 26, 263–301.
20. Milenkovic, V.M.; Krejcova, S.; Reichhart, N.; Wagner, A.; Strauss, O. Interaction of bestrophin-1 and Ca2+ channel β-subunits: Identification of new binding domains on the bestrophin-1 C-terminus. PLoS ONE 2011, 6, e19364.
21. Kalluri, R. EMT: When epithelial cells decide to become mesenchymal-like cells. J. Clin. Investig. 2009, 119, 1417–1419.
22. Bhutto, I.A.; McLeod, D.S.; Hasegawa, T.; et al. Pigment epithelium-derived factor (PEDF) and vascular endothelial growth factor (VEGF) in aged human choroid and eyes with age-related macular degeneration. Exp. Eye Res. 2006, 82, 99–110.
23. Singh, M.; Yelle, N.; Venugopal, C.; Singh, S.K. EMT: Mechanisms and therapeutic implications. Pharmacol. Ther. 2018, 182, 80–94.
24. Nieto, M.A.; Huang, R.Y.; Jackson, R.A.; Thiery, J.P. EMT: 2016. 2016, 166, 21–45.
25. Bonente, D.; Bianchi, L.; De Salvo, R.; et al. Co-Expression of Podoplanin and CD44 in Proliferative Vitreoretinopathy Epiretinal Membranes. Int. J. Mol. Sci. 2023, 24, 9728. https://doi.org/10.3390/ijms24119728.
26. Dongre, A.; Weinberg, R.A. New insights into the mechanisms of epithelial-mesenchymal transition and implications for cancer. Nat. Rev. Mol. Cell Biol. 2019, 20, 69–84.
27. Baudouin, C.; Fredj-Reygrobellet, D.; Gordon, W.C.; et al. Immunohistologic study of epiretinal membranes in proliferative vitreoretinopathy. Am. J. Ophthalmol. 1990, 110, 593–598.
28. Esser, P.; Heimann, K.; Wiedemann, P. Macrophages in proliferative vitreoretinopathy and proliferative diabetic retinopathy: Differentiation of subpopulations. Br. J. Ophthalmol. 1993, 77, 731–733.
29. Charteris, D.G.; Hiscott, P.; Grierson, I.; Lightman, S.L. Proliferative vitreoretinopathy. Lymphocytes in epiretinal membranes. Ophthalmology 1992, 99, 1364–1367.
30. Charteris, D.G. Proliferative vitreoretinopathy: Pathobiology, surgical management, and adjunctive treatment. Br. J. Ophthalmol. 1995, 79, 953–960.
31. Chaudhary, R.; Scott, R.A.H.; Wallace, G.; et al. Inflammatory and Fibrogenic Factors in Proliferative Vitreoretinopathy Development. Transl. Vis. Sci. Technol. 2020, 9, 23.
32. Lei, H.; Velez, G.; Hovland, P.; et al. Growth factors outside the PDGF family drive experimental PVR. Investig. Ophthalmol. Vis. Sci. 2009, 50, 3394–3403.
33. Ricker, L.J.; Kessels, A.G.; de Jager, W.; et al. Prediction of proliferative vitreoretinopathy after retinal detachment surgery: Potential of biomarker profiling. Am. J. Ophthalmol. 2012, 154, 347–354.e2.
34. Banerjee, P.J.; Quartilho, A.; Bunce, C.; et al. Slow-Release Dexamethasone in Proliferative Vitreoretinopathy: A Prospective, Randomized Controlled Clinical Trial. Ophthalmology 2017, 124, 757–767.
35. Andrews, A.; Balciunaite, E.; Leong, F.L.; et al. Platelet-derived growth factor plays a key role in proliferative vitreoretinopathy. Investig. Ophthalmol. Vis. Sci. 1999, 40, 2683–2689.
36. Cui, J.Z.; Chiu, A.; Maberley, D.; et al. Stage specificity of novel growth factor expression during development of proliferative vitreoretinopathy. Eye 2007, 21, 200–208.
37. Terasaki, H.; Kase, S.; Shirasawa, M.; et al. TNF-α decreases VEGF secretion in highly polarized RPE cells but increases it in non-polarized RPE cells related to crosstalk between JNK and NF-κB pathways. PLoS ONE 2013, 8, e69994.
38. Kutty, R.K.; Samuel, W.; Boyce, K.; et al. Proinflammatory cytokines decrease the expression of genes critical for RPE function. Mol. Vis. 2016, 22, 1156–1168.
39. Shirasawa, M.; Sonoda, S.; Terasaki, H.; et al. TNF-α disrupts morphologic and functional barrier properties of polarized retinal pigment epithelium. Exp. Eye Res. 2013, 110, 59–69.
40. Hinton, D.R.; He, S.; Jin, M.L.; Barron, E.; Ryan, S.J. Novel growth factors involved in the pathogenesis of proliferative vitreoretinopathy. Eye 2002, 16, 422–428.
41. Dieudonné, S.C.; La Heij, E.C.; Diederen, R.M.; et al. Balance of vascular endothelial growth factor and pigment epithelial growth factor prior to development of proliferative vitreoretinopathy. Ophthalmic Res. 2007, 39, 148–154.
42. Limb, G.A.; Alam, A.; Earley, O.; et al. Distribution of cytokine proteins within epiretinal membranes in proliferative vitreoretinopathy. Curr. Eye Res. 1994, 13, 791–798.
43. Hui, Y.; Shi, Y.; Zhang, X.; Yang, K.; Yu, C. [TNF-alpha, IL-8 and IL-6 in the early inflammatory stage of experimental PVR model induced by macrophages]. Zhonghua Yan Ke Za Zhi 1999, 35, 140–143.
44. Asaria, R.H.; Kon, C.H.; Bunce, C.; et al. Silicone oil concentrates fibrogenic growth factors in the retro-oil fluid. Br. J. Ophthalmol. 2004, 88, 1439–1442.
45. La Heij, E.C.; van de Waarenburg, M.P.; Blaauwgeers, H.G.; et al. Basic fibroblast growth factor, glutamine synthetase, and interleukin-6 in vitreous fluid from eyes with retinal de-tachment complicated by proliferative vitreoretinopathy. Am. J. Ophthalmol. 2002, 134, 367–375.
46. Mukherjee, S.; Guidry, C. The insulin-like growth factor system modulates retinal pigment epithelial cell tractional force generation. Investig. Ophthalmol. Vis. Sci. 2007, 48, 1892–1899.
47. Morino, I.; Hiscott, P.S.; McKechnie, N.; Grierson, I. Variation in epiretinal membrane components with clinical duration of the proliferative tissue. Br. J. Ophthalmol. 1990, 74, 393–399.
48. Campochiaro, P.A.; Jerdan, J.A.; Glaser, B.M.; Cardin, A.; Michels, R.G. Vitreous aspirates from patients with proliferative vitreoretinopathy stimulate retinal pigment epithelial cell migration. Arch. Ophthalmol. 1985, 103, 1403–1405.
49. Hiscott, P.; Waller, H.A. ; Grierson, I.; Butler, M.G.; Scott, D. Local production of fibronectin by ectopic human retinal cells. Cell Tissue Res. 1992, 267, 185–192.
50. Kon, C.H.; Occleston, N.L.; Charteris, D.; et al. A prospective study of matrix metalloproteinases in proliferative vitreoretinopathy. Investig. Ophthalmol. Vis. Sci. 1998, 39, 1524–1529.
51. Dvashi, Z.; Goldberg, M.; Adir, O.; Shapira, M.; Pollack, A. TGF-β1 induced transdifferentiation of rpe cells is mediated by TAK1. PLoS ONE. 2015, 10, e0122229.
52. Proulx, S.; Guérin, S.L.; Salesse, C. Effect of quiescence on integrin alpha5beta1 expression in human retinal pigment epithelium. Mol. Vis. 2003, 9, 473–481.
53. Miller, C.G.; Budoff, G.; Prenner, J.L.; Schwarzbauer, J.E. Fibronectin in retinal disease. Exp. Biol. Med. 2017, 242, 1–7. https://doi. org/10.1177/1535370216675245.
54. Tosi, G.M.; Marigliani, D.; Romeo, N.; Toti, P. Disease Pathways in Proliferative Vitreoretinopathy: An Ongoing Challenge. J. Cell. Physiol. 2014, 229, 1577–1583. https://doi.org/10.1002/jcp.24606.
55. Khankan, R.; Oliver, N.; He, S.; Ryan, S.J.; Hinton, D.R. Regulation of fibronectin-EDA through CTGF domain-specific inter-actions with TGF-β2 and its receptor TGF-βRII. Investig. Ophthalmol. Vis. Sci. 2011, 52, 5068–5078.
56. Hiscott, P.; Waller, H.A.; Grierson, I.; Butler, M.G.; Scott, D. Local production of fibronectin by ectopic human retinal cells. Cell Tissue Res. 1992, 267, 185–192.
57. Carpineto, P.; Aharrh-Gnama, A.; Ciciarelli, V.; et al. Subretinal Fluid Levels of Signal-Transduction Proteins and Apoptosis Molecules in Macula-Off Retinal Detachment Under-going Scleral Buckle Surgery. Investig. Ophthalmol. Vis. Sci. 2016, 57, 6895–6901.
58. Kawahara, S.; Hata, Y.; Kita, T.; et al. Potent inhibition of cicatricial contraction in proliferative vitreoretinal diseases by statins. Diabetes 2008, 57, 2784–2793.
59. Kon, C.H.; Occleston, N.L.; Aylward, G.W.; Khaw, P.T. Expression of vitreous cytokines in proliferative vitreoretinopathy: A prospective study. Investig. Ophthalmol. Vis. Sci. 1999, 40, 705–712.
60. Flanders, K.C. Smad3 as a mediator of the fibrotic response. Int. J. Exp. Pathol. 2004, 85, 47–64.
61. Saika, S.; Yamanaka, O.; Flanders, K.C.; et al. Epithelial-mesenchymal transition as a therapeutic target for prevention of ocular tissue fibrosis. Endocr. Metab. Immune Disord. Drug Targets 2008, 8, 69–76.
62. Saika, S.; Yamanaka, O.; Nishikawa-Ishida, I.; et al. Effect of Smad7 gene overexpression on transforming growth factor beta-induced retinal pigment fibrosis in a proliferative vitreoretinopathy mouse model. Arch. Ophthalmol. 2007, 125, 647–654.
63. Frangogiannis, N. Transforming growth factor-β in tissue fibrosis. J. Exp. Med. 2020, 217, e20190103.
64. Connor, T.B., Jr.; Roberts, A.B.; Sporn, M.B.; et al. Correlation of fibrosis and transforming growth factor-beta type 2 levels in the eye. J. Clin. Investig. 1989, 83, 1661–1666.
65. Pennock, S.; Haddock, L.J.; Mukai, S.; Kazlauskas, A. Vascular endothelial growth factor acts primarily via platelet-derived growth factor receptor α to promote proliferative vitreoretinopathy. Am. J. Pathol. 2014, 184, 3052–3068.
66. Lei, H.; Rhéaume, M.A.; Velez, G.; Mukai, S.; Kazlauskas, A. Expression of PDGFRα is a determinant of the PVR potential of ARPE19 cells. Investig. Ophthalmol. Vis. Sci. 2011, 52, 5016–5021.
67. Lei, H.; Velez, G.; Kazlauskas, A. Pathological signaling via platelet-derived growth factor receptor {alpha} involves chronic activation of Akt and suppression of p53. Mol. Cell Biol. 2011, 31, 1788–1799.
68. Wang, C.H.; Cao, G.F.; Jiang, Q.; Yao, J. TNF-α promotes human retinal pigment epithelial (RPE) cell migration by inducing matrix metallopeptidase 9 (MMP-9) expression through activation of Akt/mTORC1 signaling. Biochem. Biophys. Res. Commun. 2012, 425, 33–38.
69. Rojas, J.; Fernandez, I.; Pastor, J.C.; et al. A genetic case-control study confirms the implication of SMAD7 and TNF locus in the development of proliferative vitreoretinopathy. Investig. Ophthalmol. Vis. Sci. 2013, 54, 1665–1678.
70. Gutierrez, M.T.; Ruiz-Moreno, J.M.; Rocha-Sousa, A.; et al. The p53 codon 72 polymorphism (rs1042522) is associated with proliferative vitre-oretinopathy: The Retina 4 Project. Ophthalmology 2013, 120, 623–628.
71. Chang, C.J.; Lai, W.W.; Edward, D.P.; Tso, M.O. Apoptotic photoreceptor cell death after traumatic retinal detachment in humans. Arch. Ophthalmol. 1995, 113, 880–886.
72. Lavrik, I.N.; Golks, A.; Krammer, P.H. Caspases: Pharmacological manipulation of cell death. J. Clin. Investig. 2005, 115, 2665–2672.
73. Cook, B.; Lewis, G.P.; Fisher, S.K.; Adler, R. Apoptotic photoreceptor degeneration in experimental retinal detachment. Investig. Ophthalmol. Vis. Sci. 1995, 36, 990–996.
74. Lo, A.C.; Woo, T.T.; Wong, R.L.; Wong, D. Apoptosis and other cell death mechanisms after retinal detachment: Implications for photoreceptor rescue. Ophthalmologica 2011, 226 (Suppl. 1), 10–17.
75. Eastlake, K.; Banerjee, P.J.; Angbohang, A.; et al. Müller glia as an important source of cytokines and inflammatory factors present in the gliotic retina during proliferative vitreoretinopathy. Glia 2016, 64, 495–506.
76. Hui, Y.N.; Sorgente, N.; Ryan, S.J. Posterior vitreous separation and retinal detachment induced by macrophages. Graefes Arch. Clin. Exp. Ophthalmol. 1987, 225, 279–284.
77. Fischer, A.J.; Zelinka, C.; Milani-Nejad, N. Reactive retinal microglia, neuronal survival, and the formation of retinal folds and detachments. Glia 2015, 63, 313–327.
78. Wickham, L.; Charteris, D.G. Glial cell changes of the human retina in proliferative vitreoretinopathy. Dev. Ophthalmol. 2009, 44, 37–45.
79. Pastor, J.C.; Mendez, M.C.; de la Fuente, M.A.; et al. Intraretinal immunohistochemistry findings in proliferative vitreoretinopathy with retinal shortening. Ophthalmic Res. 2006, 38, 193–200.
80. Walshe, R.; Esser, P.; Wiedemann, P.; Heimann, K. Proliferative retinal diseases: Myofibroblasts cause chronic vitreoretinal traction. Br. J. Ophthalmol. 1992, 76, 550–552.
81. Umazume, K.; Barak, Y.; McDonald, K.; et al. Proliferative vitreoretinopathy in the Swine—A new model. Investig. Ophthalmol. Vis. Sci. 2012, 53, 4910–4916.
82. Glaser, B.M.; Cardin, A.; Biscoe, B. Proliferative vitreoretinopathy. The mechanism of development of vitreoretinal traction. Ophthalmology 1987, 94, 327–332.
83. Carpineto, P.; Di Filippo, E.S.; Aharrh Gnama, A.; t al. MicroRNA Expression in Subretinal Fluid in Eyes Affected by Rhegmatogenous Retinal Detachment. Int. J. Mol. Sci. 2023, 24, 3032. https://doi.org/10.3390/ijms24033032.
84. Toro, M.D.; Reibaldi, M.; Avitabile, T.; et al. MicroRNAs in the Vitreous Humor of Patients with Retinal Detachment and a Different Grading of Proliferative Vitreoretinopathy: A Pilot Study. Transl. Vis. Sci. Technol. 2020, 9, 23. https://doi.org/10.1167/ tvst.9.6.23.
85. Lean, J.S.; Stern, W.H.; Irvine, A.R.; Azen, S.P. Classification of proliferative vitreoretinopathy used in the silicone study. The Silicone Study Group. Ophthalmology 1989, 96, 765–771.
86. Machemer, R.; Aaberg, T.M.; Freeman, H.M.; et al. An updated classification of retinal detachment with proliferative vitreoretinopathy. Am. J. Ophthalmol. 1991, 112, 159–165.
87. Di Lauro, S.; Kadhim, M.R.; Charteris, D.G.; Pastor, J.C. Classifications for proliferative vitreoretinopathy (PVR): An analysis of their use in publications over the last 15 years. J. Ophthalmol. 2016, 2016, 7807596.
88. Pastor, J.C. Proliferative vitreoretinopathy: An overview. Surv. Ophthalmol. 1998, 43, 3–18.
89. Moysidis, S.N.; Thanos, A.; Vavvas, D.G. Mechanisms of inflammation in proliferative vitreoretinopathy: From bench to bedside. Mediat. Inflamm. 2012, 2012, 815937.
90. Pastor, J.C.; Rodríguez, E.; Marcos, M.A.; Lopez, M.I. Combined pharmacologic therapy in a rabbit model of proliferative vitreoretinopathy (PVR). Ophthalmic Res. 2000, 32, 25–29.
91. Ahmadieh, H.; Feghhi, M.; Tabatabaei, H.; et al. Triamcinolone acetonide in silicone filled eyes as adjunctive treatment for proliferative vitreoretinopathy: A randomized clinical trial. Ophthalmology 2008, 115, 1938–1943.
92. Yamakiri, K.; Sakamoto, T.; Noda, Y.; et al. One-year results of a multicenter controlled clinical trial of triamcinolone in pars plana vitrectomy. Graefes Arch. Clin. Exp. Ophthalmol. 2008, 246, 959–966.
93. Williams, R.G.; Chang, S.; Comaratta, M.R.; Simoni, G. Does the presence of heparin and dexamethasone in the vitrectomy infusate reduce reproliferation in proliferative vitreoretinopathy? Graefes Arch. Clin. Exp. Ophthalmol. 1996, 234, 496–503.
94. Banerjee, P.J.; Quartilho, A.; Bunce, C.; et al. Slow-release dexamethasone in proliferative vitreoretinopathy: A prospective, randomized controlled clinical trial. Ophthalmology 2017, 124, 757–767.
95. Dehghan, M.H.; Ahmadieh, H.; Soheilian, M.; et al. Effect of oral prednisolone on visual outcomes and complications after scleral buckling. Eur. J. Ophthalmol. 2010, 20, 419–423.
96. Koerner, F.; Koener-Stiefbold, U.; Garweg, J.G. Systemic corticosteroids reduce the risk of cellophane membranes after retinal detachment surgery: A prospective randomized placebo-controlled double-blind clinical trial. Graefes Arch. Clin. Exp. Oph-thalmol. 2012, 250, 981–987.
97. Wickham, L.; Bunce, C.; Wong, D.; McGurn, D.; Charteris, D.G. Randomized controlled trial of combined 5-Fluorouracil and low-molecular-weight heparin in the management of unselected rhegmatogenous retinal detachment sunder going primary vitrectomy. Ophthalmology 2007, 114, 698–704.
98. Yu, Z.; Ma, S.; Wu, M.; Cui, H.; et al. Self-assembling hydrogel loaded with 5-FU PLGA microspheres as a novel vitreous substitute for proliferative vitreoretinopathy. J. Biomed. Mater. Res. A 2020, 108, 2435–2446. https://doi.org/10.1002/jbm.a.36995.
99. Karakaya, M.; Albayrak, S.; Pehlivanoglu, S.; Ozkaya, A.; Gocgil, N.A. 5-Fluorouracyl added infusion fluid in patients with recurrent rhegmatogeneous retinal detachment. Saudi J. Ophthalmol. 2019, 33, 56–60.
100. Wang, Y.S.; Hui, Y.N.; Wiedemann, P. Role of apoptosis in the cytotoxic effect mediated by daunorubicin in cultured human retinal pigment epithelial cells. J. Ocul. Pharmacol. Ther. 2002, 18, 377–387.
101. Hui, Y.N.; Hu, D. Prevention of experimental proliferative vitreoretinopathy with daunomycin and triamcinolone based on the time course of the disease. Graefes Arch. Clin. Exp. Ophthalmol. 1999, 237, 601–605.
102. Wiedemann, P.; Hilgers, R.D.; Bauer, P.; Heimann, K.; Daunomycin Study Group. Adjunctive daunorubicin in the treatment of proliferative vitreoretinopathy: Results of a multicenter clinical trial. Am. J. Ophthalmol. 1998, 126, 550559.
103. Hou, H.; Huffman, K.; Rios, S.; et al. A Novel Approach of Daunorubicin Application on Formation of Proliferative Retinopathy Using a Porous Silicon Controlled Delivery System: Pharmacodynamics. Investig. Ophthalmol. Vis. Sci. 2015, 56, 2755–2763.
104. Kuo, H.K.; Chen, Y.H.; Wu, P.C.; et al. Attenuated glial reaction in experimental proliferative vitreoretinopathy treated with liposomal doxorubicin. Investig. Ophthalmol. Vis. Sci. 2012, 53, 3167–3174.
105. Mandava, N.; Blackburn, P.; Paul, D.B.; et al. Ribozyme to proliferating cell nuclear antigen to treat proliferative vitreoretinopathy. Investig. Ophthalmol. Vis. Sci. 2002, 43, 3338–3348.
106. Schiff, W.M.; Hwang, J.C.; Ober, M.D.; et al. Safety and efficacy assessment of chimeric ribozyme to proliferating cell nuclear antigen to prevent recurrence of proliferative vitreoretinopathy. Arch. Ophthalmol. 2007, 125, 1161–1167.
107. Pennock, S.; Kim, D.; Mukai, S.; et al. Ranibizumab is a potential prophylaxis for proliferative vitreoretinopathy, a nonangiogenic blinding disease. Am. J. Pathol. 2013, 182, 1659–1670.
108. Ghasemi Falavarjani, K.; Hashemi, M.; Modarres, M.; Hadavand Khani, A. Intrasilicone oil injection of bevacizumab at the end of retinal reattachment surgery for severe proliferative vitreoretinopathy. Eye 2014, 28, 576–580.
109. Tousi, A.; Hasanpour, H.; Soheilian, M. Intravitreal injection of bevacizumab in primary vitrectomy to decrease the rate of retinal redetachment: A randomized pilot study. J. Ophthalmic. Vis. Res. 2016, 11, 271–276.
110. Chang, Y.-C.; Hu, D.-N.; Wu, W.-C. Effect of oral 13-cis-retinoic acid treatment on postoperative clinical outcome of eyes with proliferative vitreoretinopathy. Am. J. Ophthalmol. 2008, 146, 440–446.
111. Schaub, F.; Abdullatif, A.M.; Fauser, S. Proliferative Vitreoretinopathieprophylaxe: Mission (im)possible [Proliferative vitreoretinopathy prophylaxis : Mission (im)possible]. Ophthalmologe 2021, 118, 3–9.
112. Amarnani, D.; Machuca-Parra, A.I.; Wong, L.L.; et al. Effect of methotrexate on an in vitro patient-derived model of proliferative vitreoretinopathy. Investig. Ophthalmol. Vis. Sci. 2017, 58, 3940–3949.
113. Sadaka, A.; Sisk, R.A.; Osher, J.M.; et al. Intravitreal methotrexate infusion for proliferative vitreoretinopathy. Clin. Ophthalmol. 2016, 10, 1811–1817.
114. Benner, J.D.; Dao, D.; Butler, J.W.; Hamill, K.I. Intravitreal methotrexate for the treatment of proliferative vitreoretinopathy. BMJ Open Ophthalmol. 2019, 4, e000293.
115. Hardwig, P.W.; Pulido, J.S.; Bakri, S.J. The safety of intraocular methotrexate in silicone filled eyes. Retina 2008, 28, 1082–1086.
116. El Baha, S.; Leila, M.; Amr, A.; Lolah, M.M.A. Anatomical and Functional Outcomes of Vitrectomy with/without Intravitreal Methotrexate Infusion for Management of Proliferative Vitreoretinopathy Secondary to Rhegmatogenous Retinal Detachment. J. Ophthalmol. 2021, 2021, 3648134.
117. Ullah, A.; Toth, C.A.; Burnett, H.W.; et al. Low-Dose Intravitreal Methotrexate for Proliferative Vitreoretinopathy. Ophthalmic Surg. Lasers Imaging Retina 2023, 54, 139–146.
118. Lemor, M.; de Bustros, S.; Glaser, B.M. Low-dose colchicine inhibits astrocyte, fibroblast, and retinal pigment epithelial cell migration and proliferation. Arch. Ophthalmol. 1986, 4, 1223–1225.
119. Liang, C.M.; Tai, M.C.; Chang, Y.H.; et al. Glucosamine inhibits epitheli-al-to-mesenchymal transition and migration of retinal
pigment epithelium cells in culture and morphologic changes in a mouse model of proliferative vitreoretinopathy. Acta Ophthalmol. 2011, 89, e505–e514.
120. Machado, R.A.; Casella, A.M.; Malaguido, M.R.; Oguido, A.P. Experimental study of vitreoretinal proliferation inhibition by the use of hypericin. Arq. Bras. Oftalmol. 2009, 72, 650–654.
121. Imai, K.; Loewenstein, A.; Koroma, B.; Grebe, R.; de Juan, E., Jr. Herbimycin A in the treatment of experimental proliferative vitreoretinopathy: Toxicity and efficacy study. Graefes Arch. Clin. Exp. Ophthalmol. 2000, 238, 440–447.
122. Eibl, K.H.; Lewis, G.P.; Betts, K.; et al. The effect of alkylphosphocholines on intraretinal proliferation initiated by experimental retinal detachment. Investig. Ophthalmol. Vis. Sci. 2007, 48, 1305–1311.
123. Zheng, Y.; Ikuno, Y.; Ohj, M.; et al. Platelet-derived growth factor receptor kinase inhibitor AG1295 and inhibition of experimental proliferative vitreoretinopathy. Jpn. J. Ophthalmol. 2003, 47, 158–165.
124. Lei, H.; Velez, G.; Cui, J.; et al. N-acetylcysteine suppresses retinal detachment in an experimental model of proliferative vitreoretinopathy. Am. J. Pathol. 2010, 177, 132–140.
125. Ma, G.; Duan, Y.; Huang, X.; et al. Prevention of Proliferative Vitreoretinopathy by Suppression of Phosphatidylinositol 5-Phosphate 4-Kinases. Investig. Ophthalmol. Vis. Sci. 2016, 57, 3935–3943; Erratum in Investig. Ophthalmol. Vis. Sci. 2016, 57, 4213.
126. Alex, A.F.; Spitznas, M.; Tittel, A.P.; Kurts, C.; Eter, N. Inhibitory effect of epigallocatechin gallate (EGCG), resveratrol, and curcumin on proliferation of human retinal pigment epithelial cells in vitro. Curr. Eye Res. 2010, 35, 1021–1033.
127. Chen, C.L.; Chen, Y.H.; Tai, M.C.; et al. Resveratrol inhibits transforming growth factor-β2-induced epithelial-to-mesenchymal transition in human retinal pigment epithelial cells by suppressing the Smad pathway. Drug Des. Dev. Ther. 2017, 11, 163–173.
128. Tura, A.; Schuettauf, F.; Monnier, P.P.; Bartz-Schmidt, K.U.; Henke-Fahle, S. Efficacy of Rho-kinase inhibition in promoting cell survival and reducing reactive gliosis in the rodent retina. Investig. Ophthalmol. Vis. Sci. 2009, 50, 452–461.
129. Halász, É.; Townes-Anderson, E.; Zarbin, M.A. Improving outcomes in retinal detachment: The potential role of rho-kinase inhibitors. Curr. Opin. Ophthalmol. 2020, 31, 192–198.
130. Lewis, G.P.; Chapin, E.A.; Byun, J.; et al. Müller cell reactivity and photoreceptor cell death are reduced after experimental retinal detachment using an inhibitor of the Akt/mTOR pathway. Investig. Ophthalmol. Vis. Sci. 2009, 50, 4429–4435.
131. Tseng, S.C. HC-HA/PTX3 Purified from Amniotic Membrane as Novel Regenerative Matrix: Insight into Relationship Between Inflammation and Regeneration. Investig. Ophthalmol. Vis. Sci. 2016, 57, ORSFh1–8.
132. He, H.; Kuriyan, A.E.; Su, C.W.; et al. Inhibition of Proliferation and Epithelial Mesenchymal Transition in Retinal Pigment Epithelial Cells by Heavy Chain-Hyaluronan/Pentraxin 3. Sci. Rep. 2017, 7, 43736.
133. Yang, S.F.; Chen, Y.S.; Chien, H.W.; et al. Melatonin attenuates epidermal growth factor-induced cathepsin S expression in ARPE-19 cells: Implications for proliferative vitreoretinopathy. J. Pineal Res. 2020, 68, e12615.
134. Carrington, L.; McLeod, D.; Boulton, M. IL-10 and antibodies to TGF-beta2 and PDGF inhibit RPE-mediated retinal contraction. Investig. Ophthalmol. Vis. Sci. 2000, 41, 1210–1216.
135. Coffee, R.E.; Jiang, L.; Rahman, S.A. Proliferative vitreoretinopathy: Advances in surgical management. Int. Ophthalmol. Clin. 2014, 54, 91–109.
136. Iwahashi-Shima, C.; Sato, T.; Bando, H.; Ikeda, T.; Emi, K. Anatomic and functional outcomes of 25- gauge vitrectomy for repair of eyes with rhegmatogenous retinal detachment complicated by proliferative vitreoretinopathy. Clin. Ophthalmol. 2013, 7, 2043–2049.
137. Minarcik, J.R.; von Fricken, M.A. Virtual retinectomy: Indocyanine green-assisted internal limiting membrane peeling as a surgical adjunct in repair of recurrent rhegmatogenous retinal detachment due to PVR. Clin. Ophthalmol. 2012, 6, 631–636.
138. Rao, R.C.; Blinder, K.J.; Smith, B.T.; Shah, G.K. Internal limiting membrane peeling for primary rhegmatogenous retinal detachment repair. Ophthalmology 2013, 120, 1102–1103.e1–2.
139. Akiyama, K.; Fujinami, K.; Watanabe, K.; Tsunoda, K.; Noda, T. Internal Limiting Membrane Peeling to Prevent Post-vitrectomy Epiretinal Membrane Development in Retinal Detachment. Am. J. Ophthalmol. 2016, 171, 1–10.
140. Foveau, P.; Leroy, B.; Berrod, J.-P.; Conart, J.-B. Internal Limiting Membrane Peeling in Macula-off Retinal Detachment Complicated by Grade B Proliferative Vitreoretinopathy. Am. J. Ophthalmol. 2018, 191, 1–6.
141. Shroff, D.; Saha, I.; Bhatia, G.; et al. Tug of war: A bimanual technique for anterior circumferential proliferative vitreoretinopathy in recurrent retinal detachment. Indian J. Ophthalmol. 2020, 68, 2155–2158.
142. Abrams, G.W.; Azen, S.P.; McCuen, B.W.; et al. Vitrectomy with silicone oil or long-acting gas in eyes with severe proliferative vitreoretinopathy: Results of additional and long-term follow-up. Silicone Study report 11. Arch. Ophthalmol. 1997, 115, 335–344.
143. Storey, P.; Alshareef, R.; Khuthaila, M.; et al; Wills PVR Study Group. Pars plana vitrectomy and scleral buckle versus pars plana vitrectomy alone for patients with rhegmatogenous retinal detachment at high risk for proliferative vitreoretinopathy. Retina 2014, 34, 1945–1951.
144. Kasetty, V.M.; Aye, J.; Patel, N.; et al. Outcomes and complications of primary rhegmatogenous retinal detachment repair with pars plana vitrectomy in young adults. Int. J. Retina Vitr. 2023, 9, 11.
145. Caporossi, T.; Molle, A.; Carlà, M.M.; et al. Applications of Human Amniotic Membrane Patching Assisted Vitrectomy in the Management of Postoperative PVR in Com-plex Retinal Detachments. J. Clin. Med. 2023, 12, 1137.
146. Zuzic, M.; Rojo Arias, J.E.; Wohl, S.G.; Busskamp, V. Retinal miRNA Functions in Health and Disease. Genes 2019, 10, 377.
Neuro-ophthalmology
Pediatric ophthalmology, refractive errors and amblyopia
Ocular injuries
Systemic ophthalmology
Arturo Carta, Roberta Farci
Optic neuritis
Optic neuritis (ON) is an inflammation of the optic nerve which typically produces an acute, painful visual loss generally occurring in an otherwise healthy young patient.
There is a clear female predisposition (about 3:1) and 92% of the patients have periocular pain in the innervation territory of the first trigeminal branch, exacerbated by eye movements. Patients also report dyschromatopsia, decreased contrast sensitivity and colour desaturation. Other visual symptoms may be represented by the Uhthoff’s phenomenon and the Pulfrich effect: Uhthoff’s phenomenon is a worsening of visual function due to excessive changes in body or environmental temperature or physical effort whereas the Pulfrich effect is loss of stereopsis of moving objects.
The pathognomonic objective sign of optic neuritis is an ipsilateral relative afferent pupillary defect (RAPD) in unilateral cases. Anterior inflammation of the optic nerve is called Papillitis (30% of cases) and is always associated in the acute phase with an inflamed and swollen optic disc on funduscopy (Figure 1). Retrobulbar optic neuritis (NORB) occurs in most cases (70%) when there is an involvement of the posterior two thirds of the optic nerve.
The diagnosis of ON is clinical1. However, the confirmation of our diagnosis needs an important systemic work-up of the patient that must be managed by an appropriate multidisciplinary team of specialists. The aim of such work-up is to identify the systemic (mainly neurological) causes responsible for ON. We strongly recommend performing ophthalmological and non-ophthalmological investigations on patients presenting with an inflamed optic nerve as soon as possible to avoid prolonged misdiagnosis.

Visual field examination of our patient will show a depression in the 30° area with a central scotoma (Figure 2). BCVA is usually severely reduced to 20/200 at presentation in 70% of cases. Colour vision need to be investigated because usually the patient reports dyschromatopsia as well as contrast sensitivity impairment. VEPs demonstrate a significant increase in wave p100 latency, a reduction in the amplitude of the response and a delay in retino-cortical time of conduction on the affected side.

In NORB, funduscopy and OCT are normal at onset but after 6 to 12 months we can detect a variable and diffuse amount of fibers loss (about 20%) with mild optic atrophy. After a first episode of typical ON, an almost complete recovery of the central visual function is expected after 8 to 12 weeks (the recovery is fastened if steroids therapy is intravenously administered to the patient at onset). OCT alterations may help to distinguish NeuroMielitis Optica Spectrum Disorder (NMOSD) patients from MS patients (see below in this chapter). Correlations between brain abnormalities on MRI and optic nerve damage on OCT may shed light on how damage to one part of the CNS can affect others.
Appropriate orbital MRI contrast enhanced scan is mandatory in all cases of optic neuritis, supporting our clinical diagnosis and providing a visual prognosis at baseline.
A cerebral MRI will be useful to demonstrate an association between ON and MS or other possible causative disorders (Figure 3). Cervical MRI is used to identify a transverse myelitis in bilateral cases.
We strongly suggest a neuroimaging before starting any kind of therapy when evaluating an ON at the first time. Other no-ophthalmological investigations necessary to correctly evaluate ON include a lumbar puncture (when needed), other than an accurate and appropriate serological evaluation of the patient (see for example the detection of AQp4 or Anti-MOG antibodies).
The visual prognosis for a typical monolateral ON is excellent; within 3 months there is almost complete spontaneous recovery in nearly all patients. After one year from the onset, permanent (but subclinical) deficits in contrast and colour sensitivity may be detected. Intravenous high dose steroids fasten the recovery, but do not change the final visual outcome. Recovery is accomplished in 85% of cases within 15 days and in 96% of cases within 30 days. 30% of patients will have a recurrence. In case of recurrence there is a progressive deterioration of visual function after each event (CRION). Poor baseline visual acuity is the sole predictor of a poor visual outcome (ONTT report).
The systemic prognosis depends on the underlying disease responsible for the ON and the

patient must be managed by a trained multidisciplinary team. MRI provides further visual prognostic information; optic nerve inflammation involving more than 17.5 mm and/or intracanalicular part of the nerve have partial recovery of visual function.
Risk of developing MS after ON
After a follow-up of 15 years 72% of patients with a positive MRI developed MS, instead between the one with a negative MRI the percentage of patients with MS was 25%.
Previous paresthesias increase the risk of MS in patients with a negative MRI.
In addition, the presence of oligoclonal bands has a significative positive predictive value when the MRI is negative. The percentage of subjects that develop MS increase from 4% to 27% when oligoclonal bands are found in CSF.
Low risk profile of CDMS in optic neuritis includes male sex, absence of pain at the onset, no HLA Dw2 or B7, no light perception or mild visual loss (>20/40), oedema with disc or peripapillary hemorrhages and macular exudates.
The therapy of ON in demyelinating or idiopathic disease is steroids (1gr/iv/die of methylprednisolone for 5 days). This therapy does not improve the visual outcome, that is spontaneously excellent, but it speeds up the recovery from 3 months to 15-20 days.
If the ON is caused by an infectious disease, steroid at high doses is contraindicated. Steroids induce a transitory immunodeficiency that could worsen the clinical condition of the patient and causing the spread of the pathogen and a sepsis. In this case the patient will need an antibiotic therapy.
In case of autoimmune ON, therapy is represented by immunomodulatory drugs or immune suppressive therapy and the patient must be managed by the appropriate multidisciplinary team.
Neuromyelitis optica (NMO) or Devic’s disease
Neuromyelitis optica is a demyelinating disease characterized by the association of ocular and cervical medullary symptoms first described on 1894 by the Belgian neurologist Eugene Devic.
It has an acute onset with a dramatic worsening of the visual function which is severely affected.
The symptoms are consistent with a bilateral optic neuritis (30% of cases painless) and an acute myelitis with para/tetraparesis other than sensorial and sphinteric alterations.
The typical patient is a woman (90% of cases) between 20 and 30 years old. However, the prevalence is fortunately low with 1-2 cases per 100,000 inhabitants. NMO usually is monophasic. but in 10% of cases there is a recurrence. It is often associated with SLE, Sjogren’s syndrome and myasthenia gravis.
Since two decades ago, NMO was considered by several authors as a variant of MS. Today we know that NMO is a demyelinating disorder completely different from MS. Indeed, the presence of anti-aquaporin 4 antibodies in the blood of 65-70% of patients presenting with NMO symptoms has been detected on 2004. AQP4-immunoglobulin G (IgG) binds “water channel” aquaporin-4 in the CNS and largely present in astrocytes of the optic nerves, thus playing a crucial role in the pathogenesis of the disease. AQ4-antibody seropositivity has a sensitivity for NMO of 68-91% and a specificity of 85-99%. These antibodies are positive only in 5-6% of patients with monolateral ON.
The “core” clinical characteristics of NMO are2:
1. Bilateral optic neuritis
2. Acute myelitis
3. Area postrema syndrome: episode of otherwise unexplained hiccups or nausea and vomiting
4. Acute brainstem syndrome
5. Symptomatic narcolepsy or acute diencephalic clinical syndrome with NMOSD-typical diencephalic MRI lesions
6. Symptomatic cerebral syndrome with NMOSD-typical brain lesions.
Ophthalmological Investigations
OCT shows a greater retinal fibre layer thinning in NMO-ON eyes than in MS-ON eyes, with the greatest thinning in the superior and inferior retinal nerve fibre layer quadrants. Results of one study suggested that retinal nerve fibre layer thickness loss greater than 15 µm in patients without MS should prompt investigations for NMO spectrum disorder.
Early administration of high-dose steroids preserved retinal nerve fibre layer thickness in an uncontrolled, retrospective study. Longitudinal reductions in retinal ganglion cell and inner plexiform layer thickness have also been recorded in NMO-ON eyes. Thickness of the inner nuclear layer could be increased in neuromyelitis optica.
A qualitative abnormality called microcystic oedema has been observed in the inner neuronal layer of the retina in 20% of patients with neuromyelitis optica and about of 5% of those with MS.
VF examination is very difficult to perform on NMO patients as their BCVA is severely reduced and they may suffer neurological symptoms.
Differential diagnosis
It is very important to distinguish between NMO and MS because THESE ARE DIFFERENT DISEASES which need different treatment SINCE THE DIAGNOSIS IS QUICKLY MADE. In NMO immunosuppressants are more effective than immunomodulatory therapy (such as interferon-β). In several cases it was demonstrated that interferon-β may increase disease activity. Rituximab seems to be one of the most promising drugs in NMO and this treatment may therefore be considered in severe ON, associated with positive AQP-4 antibodies.
Prognosis is variable, after some episodes we can have spontaneous resolution, even if often there are neurological deficits, which can be severe (Figure 4). A high percentage of patients completely loses the vision in one or both eyes or experiments permanent paraparesis. Unfortunately, 8% of subjects (14% if Afro-Brazilian or Afro-American) may die within 5 years from the onset of NMO due to paraplegia and respiratory failure secondary to intense episodes of myelitis.
The effects of a prompt therapy with long active agents are unknown, but it has been observed that the episodes are reduced by a 50% with an effective immunosuppressive treatment.
Therapy
Treatment in acute consists of steroids i.v., plasmapheresis, and rituximab; new agents are under investigation at this time.

Myelin Olygodendrocyte Glycoprotein antibody-associated disease (MOGAD).
This is a new demyelinating disorder whose autoimmune pathogenesis has been recently demonstrated: the diagnostic criteria has been reported in a Consensus Conference on 20233 We strongly recommend testing for MOGAD as an important percentage of bilateral optic neuritis which are seronegative for AQP4-IgG may be positive to MOG autoantibodies. In particular, patients with relapsing-remitting ON may show this positivity or those who have optic perineuritis/orbital inflammation on MRI scan at first presentation. As MOG is a different demyelinating disease from MS and NMO, we strongly recommend simultaneous testing for AQP4 and MOG autoantibodies in the initial work-up of a patient presenting with a mono- or bilateral ON.
Inflammation of the optic nerve may have an infectious aetiology. Infectious optic neuropathies are caused by the spread of an infectious process for continuity or contiguity. Parainfectious optic neuropathies have a delayed immune-mediated pathogenesis. They require a multidisciplinary management.
The symptoms include an acute visual loss, pain in the area innervated by the ophthalmic branch of trigeminal nerve, associated to fever and previous systemic or neurological symptoms.
It can be uni- or bilateral.
It is more frequent in the paediatric or immunodepressed patient. The aetiology of infectious optic neuropathies may include:
• Infectious meningitis and/or encephalitis
• Tuberculosis
• Syphilis
• Toxoplasmosis
• Herpes Simplex, Herpes Zoster
• Lyme Disease
• Leber’s idiopathic stellate neuroretinitis
• Bacterial sinusitis
• Fungal sinusitis
• Arthropod-borne viruses: West Nile and Chikungunya
• Citomegalovirus
In case of Lyme Disease, eye involvement is always symptomatic, and it is recommended to perform a routine assessment in paediatric patients.
A rational suspicion of borrelia uveitis must include at least one of the following elements: staying in endemic areas or occupations at risk, reported contact with ticks, positive serology. During long-term follow up for optic neuritis initially diagnosed caused by Borrelia (serology +) revealed that ¾ of patients developed a demyelinating disease.
Treatment consists of:
Amoxicillin: 1g x3/day for at least 3 weeks
After at least 3 days of antibiotics: i.v. steroids followed by oral steroids 0.5 mg/kg/day in slow increments.
There is an almost complete visual recovery within 2-3 months.
Ocular characteristics of West Nile Virus infection include: chorioretinitis, occlusive retinal vasculitis, uveitis and optic neuritis.
Optic neuritis is bilateral, and it has a latency time of approximately 7-10 days in comparison with the onset of systemic symptoms. The visual prognosis is 3/10-6/10.
In these patients we use topical and/or local steroids, it is difficult to establish if the treatment modified the course of the disease due to the restricted number of patients and the absence of a control.
The management of such patients must be carried on by an appropriate multidisciplinary team and foresee a customized therapy depending on the infectious agent.
Traumatic optic neuropathy (TON) is an uncommon cause of permanent visual loss. Optic nerve trauma may be direct (open wound with penetrating objects or bone fragments dislocation within the orbit) or indirect (without evidence of penetrating injuries). Optic nerve injuries may be further classified from an anatomical point of view as anterior (intraocular and anterior portion of the retrobulbar optic nerve), posterior (posterior part of the orbital optic nerve), intracanalicular and intracranial. Indirect traumatic optic neuropathy is the most common form of TON, because the orbital bones usually provide a natural protection to penetrating objects. Such patients may suffer from extremely severe visual impairment in addition to other neurological problems related to the head trauma. Although the degree of visual loss after both forms of TON may be variable, they are often severe, with approximately 50% of patients are left with ‘light perception’ or ‘no light perception’ as their final outcome. Indirect damage of the optic nerve is estimated to occur in 0.5–5% of all closed head trauma cases. When occurring in multisystem trauma with midface involvement and serious brain injury, loss of consciousness is associated with TON in 50–72% of cases.
TON must be considered as a consequence of head trauma; the entity of the trauma may be severe, but TON has often been described even in cases of minor head trauma. In cases of severe trauma, the optic neuropathy is often associated with midface fractures and with several multi- system problems responsible for the difficult management of such cases.
Motor vehicle accidents are the most frequent cause, accounting for 30–63% of cases depending on the series. Falls are the second leading cause, accounting for 20–36% of cases, whereas firearms, assaults and blows from heavy objects are the third leading cause, while work- related TBIs account for the remaining cases.
Signs & symptoms
Traumatic optic neuropathy is a clinical diagnosis suspected in the case of visual loss following a minor/major history of head trauma.
The findings of a normal visual acuity and normal visual field other than normal pupillary function are not compatible with the diagnosis of traumatic optic nerve injury.
Patients capable of providing a history complain of decreased visual acuity or visual field defects following a described minor head trauma.
Comatose patients are more difficult to manage; in these cases, orbital imaging, transpalpebral visual evoked potentials (VEPs) and pupillary dysfunction are often critical for the diagnosis.
A relative afferent pupillary defect (RAPD) indicates a unilateral or bilateral (but asymmetrical) TON. If a RAPD is not detected, the patient does not have TON unless it is bilateral and very symmetrical. In responsive patients, when TON is bilateral and very symmetrical, the presence of pupillary light-near dissociation (with the near pupillary response being brisker than the response to light) is very useful for diagnosis4.
The most common site of optic nerve damage is at the level of the optic canal, followed by the intracranial, the intraorbital and the intraocular portions. Typically, injury occurs in association with an acceleration/deceleration force that results from significant shifts in momentum. In cases of isolated TON, the forces of impact often occur to the ipsilateral forehead (glabellar) region which is considered a “TRIGGER ZONE”.
Injuries that occur in the anterior 1/3 of the nerve produce ophthalmoscopic evidence of infarction, hemorrage or central retinal artery occlusion with a cherry-red spot at the macula. Avulsion of the optic nerve from the globe produces a typical ophthalmoscopic picture of a ring of hemorrhage around the optic nerve head and obscuration of the disc margins (Figura 5). A progressive or delayed form of TON may occurs after optic nerve compression by subperiosteal or extra-nerve sheath hemorrhages; in this case proptosis and high intraocular pressure are usually associated with visual loss. Vision may continue to deteriorate after the initial insult when an intra-nerve sheath hematoma occurs. The optic disc remains normal in appearance in traumatic cases that involve the intracanalicular or intracranial portion of the nerve during the acute phase of the disease but optic atrophy begins after an 8-12 week period, irrespective of the site of damage, and this must be considered a clinical landmark of this optic neuropathy (Figure 6).


Associated ocular injuries must be evaluated and treated. Ocular injuries may overlap with the signs and symptoms of TON. Clinicians must be aware that if ocular injuries do not account for the severe degree of visual loss observed, then a TON must be suspected; in this setting, the presence of a RAPD is a clinical landmark supporting the diagnosis of TON.
High-resolution CT scanning is the gold standard in delineating fractures of the orbital bones. Contrast agents are not generally required. Particular attention should be directed to the orbital apex where bone fractures may directly damage the optic nerve by tearing or compression. A high resolution CT scan (bone window, 1.5 mm. slice) on an oblique coronal plane with 3D-multiplanar reconstruction is the ideal for evaluating optic canal fractures (Figure 7). CT is the best imaging study for detailed examination of bone fractures, detection of acute subperiostal hematoma, and for acute retrobulbar hemorrhage. Furthermore, CT provides the data required to plan surgeries such as transethmoidal optic canal decompression. MRI is superior to CT for imaging of soft tissue; as hemorrhages into the optic nerve sheaths may cause a progressive/delayed form of TON, orbital MRI should be performed when optic nerve swelling is observed on a CT scan or in the compatible clinical setting.
Flash VEPs may be of particular importance to corroborate or establish the clinical diagnosis of TON, especially in patients who are unresponsive and hospitalized in the intensive care unit when pupillary reactivity cannot be tested (pharmacological block); in such cases, VEPs may provide readily accessible information on the state of the optic nerve and serve as a guideline in the management of TON. However, their clinical utility is limited as a highly qualified technician is needed and may not be available after-hours. In the presence of unilateral or bilateral TON, VEPs are always altered and may show abnormalities that range from moderate conduction delay with reduced amplitude to complete extinction. A nonrecordable VEP is generally associated with poor negative prognosis. When sufficient vision and compliance is present, formal visual field assessment should be performed in order to better quantify the visual impairment. In our experience, there is no specific pattern of visual field alteration associated with TON; both the central and peripheral visual field could be involved, generally manifested by large absolute and irregular scotomas.

Once the diagnosis of TON has been made, we must consider a differential diagnosis with several forms of optic neuropathies.
First of all, TON may occur in combination with other ocular injuries. Multiple causes of visual loss following trauma must always be considered; if the detectable ocular alteration does not account for the severity of the observed loss of vision and for the presence of a RAPD, then TON should be suspected. In cases of isolated TON, the forces of impact often occur to the ipsilateral forehead region. It is noteworthy that in the pathogenesis of TON the site of the injury and the ‘quality’ of the kinetic forces bore to the head are more important than the overall amount of the forces per se. For this reason, minor trauma in the forehead region is frequently responsible for TON in an awake and alert patient.
The identification of prognostic signs in TON during the acute phase can have important implications, as such signs may be the criteria and serve as guidelines for the treatment of TON depending on the expected natural history outcome. Several of these prognostic signs have been determined. Cook et al., in their meta-analysis, found that orbital fractures associated with TON have a worse prognosis than in cases of no fractures and posterior fractures (in particular those involving the optic canal) have a worse prognosis than anterior ones. Chou et al. found that patients with vision better than light perception after trauma benefited more from treatment than did patients with complete visual loss. Furthermore, they found that prognosis is very dependent upon the time interval between injury and treatment. Carta A et al. found four negative prognostic signs associated with TON:
• Presence of blood within the posterior ethmoidal cells as detected on CT scan
• Age over 40 years
• Reported loss of consciousness during trauma
• Lack of improvement after 48 h of steroid treatment; 70% of the time, visual acuity is severely reduced after TON; however, the remaining visual function is important and may facilitate future activities for the patient.
Finally, we have performed a study investigating the long-term outcome of patients with indirect TON that maintained useful vision after trauma, and found that the residual visual function documented shortly after trauma was maintained indefinitely.
There is, at present, no clearly accepted standardized treatment protocol for TON. Indeed, much controversy remains concerning optimal management of TON. Therapeutical options may include observation alone, intravenous high-dose corticosteroid administration and surgical treatment. Reports of improvement have been published for each of these three options but actually there is no clear evidence that one treatment is better than the other or versus observation alone. For these reason, the optimal treatment for indirect optic nerve trauma remains controversial and management decisions tend to be made on the basis of personal preference.
Ischemic optic neuropathy is the most common acute optic neuropathy in patients over 60 years old. The ischemia of the optic nerve can be unilateral or, much more rarely, bilateral at onset.
The optic nerve may be affected anteriorly or posteriorly.
• Anterior ischemic optic neuropathy (AION): involves the anterior third of the nerve and is responsible for 90% of the overall cases.
• Posterior ischemic optic neuropathy (PION): involves the posterior two thirds of the nerve (extremely rare, 10% of cases).
Anterior ischemic optic neuropathy (AION)
This condition must be clearly distinguished from the central retinal artery occlusion. There are two types of AION: the hypoperfusive form (NAION) and the one linked to Giant Cell Arteritis (Horton’ cranial arteritis). The pathogenesis, the clinical picture, the prognosis and the therapy of these two forms of AION are completely different and they must considered as two separate diseases.
NAION is caused by an insufficient blood supply (usually occurring during the night) at the head of the optic nerve in patients with small crowded disks (hyperopia is a local risk factor) which have lost their local blood flow autoregulation as a consequence of co-existent systemic morbidities such are hypertension, diabetes, hypercoagulability and atherosclerosis. The final result is an irreversible damage of the optic nerve head circulation simulating a transient ischemic attack (TIA) without a proper vascular occlusion.
Arteritic AION (AION-Art) is caused by an occlusion of the posterior ciliary arteries at the level of the optic nerve head related to an autoimmune inflammatory process of their wall producing an almost complete retrolaminar stroke.
Posterior ischemic optic neuropathy (PION)
PION is a very rare condition consequent to the ischemia of the intra-orbital part of the optic nerve; at this level the vascularization is formed by pial penetrating vessels that enter centripetally between the nerve axons.
There are three groups of PION with different etiology:
• PION secondary to severe systemic hypoperfusion, it can be idiopathic or due to an overdose of antihypertensive therapies. This type of PION is bilateral.
• PION secondary to an autoimmune attack on the optic nerve in the course of autoimmune diseases (such as connective diseases, SLE or Horton’s syndrome) or infections.
• PION associated with severe systemic hypoperfusive states like those induced during surgery (typical during operations on the spinal cord)
Signs & symptoms
Ischemic optic neuropathies are characterized by a sudden vision loss, usually severe and not associated with trigeminal pain at the onset. The days before the ischemia the patient can experience prodromes, such as recurrent amaurosis fugax. These patients usually are vasculopathic but when the ischemia affects young people, it is commonly associated with autoimmune or coagulation disorders.
Patients with AION-Art are particularly old and may have the typical symptoms of Horton’ disease (mandibular claudication, frontal headache, arthromyalgia). This type of AION also has an extremely severe impairment of the visual function with VA reduced to less than 1/10 and the visual field almost completely abolished without possibility of improvement in the long term.
On the opposite hand, visual acuity in NAION is much more less affected (mean final BCVA outcome is 20/40) and the VF typically shows an altitudinal defect, typically in its inferior part (Figure 8). NAION has also a better prognosis than AION-Art with possible little improvements in visual function in the next two months from the onset.


In unilateral ischemic optic neuropathy there is the presence of a RAPD and the fundoscopy shows an edema of the papilla with hemorrhages, exudates, narrowing of the optic disc vessels.
Retinal fluorangiography may be helpful in differentiating between NAION and AION-Art (Figure 9) but in my opinion clinical features and the serological evidence (or not) of an extremely elevated ESR, CRP, and fibrinogen are much more accurate parameters to perform a correct diagnosis and must be immediately performed at the first visit of the patient. Horton’ disease is diagnosed performing a biopsy of the temporal artery on the affected side. The biopsy reveals an inflammatory infiltrate in the middle lamina with giant cells and fragmentation of the inner elastic lamina producing a complete occlusion of the artery5
In cases of typical AION, there is no indication to perform a cerebral MRI or CT scan on urgency.
In NAION the risk of bilateralization is of 30% within a year after the onset with a visual impairment in the second involved eye which usually is less severe than the impairment observed in the first eye affected.
AION-Art is generally simultaneously bilateral or it becomes bilateral within two weeks; this is the reason why this disease is a real neurophthalmological emergency and is mandatory that the patient goes to an ophthalmologist as soon as possible in this condition. A prompt steroidal therapy prevent the onset in the fellow eye in the majority of cases. This is extremely important because it avoids a state of legal blindness for the patient and allows him to have an almost normal relationship life.
In AION-Art the prognosis of the affected eye is very bad; after 8-12 weeks from the onset, the edema of the papilla turns into atrophy of the nerve.
PION has a terrible prognosis and actually there are no proven form of therapies. At the same time, we don’t have a proven therapy for NAION to date; such patients must perform a complete cardiovascular screening: the optimization of cardiovascular parameters and of
glycemia can reduce the risk of the disease in the fellow eye.
In AION-Art steroids MUST BE IMMEDIATELY administered in order to prevent the involvement of the fellow eye and other cerebral areas. Which dosage? Actually there are no prospective studies evaluating the best dose of steroids. So, they can be administered on a personal basis ranging from 1 mg/kg orally in the early stage or, to be more aggressive, 500 mg/die for 3-5 days iv. The management of these patients is multidisciplinary and it involves ophthalmologists, neurologists and rheumatologists in particular.
Toxic-nutritional optic neuropathy (tobacco-alcohol optic neuropathy)
Toxic-nutritional optic neuropathy is a bilateral optic neuropathy secondary to the action of exogenous substances which is exacerbated by a reduced antioxidant power of the organism, usually related to a poor and unbalanced diet.
The list of toxic agents is extremely long and these may a lot of damaging affect the optic nerve selectively or in addition with other regions of the CNS: in this latter case, the optic neuropathy is associated with other neurological symptoms.
The mechanisms of action of these agents is extremely variable: some of them may inhibit important enzymes for the cellular metabolism (methyl alcohol); some produce tissue hypoxia by direct action on arterial vessels (quinine); some act through a deficiency mechanism (Vitamin B deficiency). Another mechanism of action is a dysfunction of the mitochondrial oxidative phosphorylation (chloramphenicol, ethambutol, isoniazid). Alcohol and tobacco abuse are usually precipitating factors because they increase the oxidative stress of the cells. There must be an individual genetic predisposition to develop this pathology, although this has not been demonstrated yet. Certainly, the possible coexistence of point mutations in the mitochondrial DNA of these patients (see the pathogenesis of LHON) will aggravate the visual impairment of this disease.
Nowadays, it is rarer to find toxic neuropathies secondary to toxic working exposition, this is due to the appropriate preventive measures of occupational medicine.
Nutritional deficits (see malabsorption diseases such as beri-beri, pellagra, intestinal parasitosis by tapeworms or hookworms or Crohn’s disease) whether quantitative (insufficient dietary intake) or qualitative (diet quantitatively sufficient but lacking certain elements) usually act together with toxic substances giving as a final product a functional deficit of the optic nerve with selective degeneration of the thinnest axon fibres (the central ones of the papillo-macular bundle for this reason peripheral vision is generally preserved).
The patient reports a sub-acute decline with moderate progression of visual acuity to very low levels (20/200), bilateral, without pain, with dyschromatopsia and contrast sensitivity defect. The typical patients are middle-aged males which may show peripheral neuropathy with paresthesias of the long nerves, ataxia and hearing loss.
The fundus examination is within normal limit at the early stage of the disease; with a long lasting action of the toxic agents (usually between 4 to 6 months after the onset of the disease), funduscopy will show a selective temporal optical atrophy of the papilla with loss of papillar-macular fibers (which actually is easily confirmed on OCT evaluation of the optic nerve head). The visual field will show in the initial stages of the disease a small scotoma in the central 10° which will gradually increase in a centrifugal direction finally affecting the central 20-30° (Figure 10). The regression of the scotoma, in cases of visual recovery, will be gradual and will take place in an opposite way to its presentation6. The diagnosis of a toxic-nutritional optic neuropathy follows a criterion of exclusion of other

more common causes of bilateral visual loss; a cerebral CT-scan or MRI must be performed to exclude compression of the anterior visual pathway and to document associated encephalopathy features.
Visual evoked potentials are particularly useful confirming alterations in optic nerve conduction. The management of these patients involves a thorough anamnestic questionnaire to exclude any occupational exposure or alcohol and/or smoking abuse. The amount and composition of the diet must be thoroughly investigated
Serological tests look for exogenous toxins, while lumbar puncture with CSF analysis is another essential test for diagnostic purposes to rule out infectious elements and confirm high levels of suspected toxic agents (lead, cyanates, formic acid, etc.).
The differential diagnosis arises mainly with Leber’s juvenile optic neuropathy, which produces an absolutely similar clinical picture, as well as with simulators.
The only negative prognostic element is the finding of optic atrophy, as demonstrated by the analysis of optic nerve fibers on OCT scan. The presence of an optic atrophy at the first visit of the patients rules out the possibility of a visual recovery. In this sense, when optic atrophy is not already demonstrated, the rapidity in diagnosing and instituting treatment play a fundamental role. In addition, the duration of exposure and particularly high serological levels of any toxic substance identified (alcohol, cyanates, etc.) also have a worse visual prognosis than recent intake or exposure to borderline levels of the substances tested. If diagnosed early, if there is no state of nerve atrophy, with targeted therapeutic treatment this condition is often associated with a good recovery of visual function.
Therapy
Therapy involves the administration of folate and multivitamin complexes in deficient forms, as well as the elimination of the toxic agent if it is promptly detected. Alcohol abuse and cigarette smoking should be ruled out. Follow-up includes medical examination every three months for one year.
An heterogeneous group of optic neuropathies characterized by evidence of nuclear or mitochondrial transmission and optic atrophy as common landmark.
From an epidemiological point of view, these optic neuropathies are rare or extremely rare. For this reason, in this section we will discuss the two most common clinical entities, i.e. Leber’s Hereditary Optic Neuropathy (LHON) and Dominant Optic Atrophy (DOA or Kjer’s optic atrophy, OPA).
A rare form of optic neuropathy characterized by a bilateral painless and almost symmetrical severe loss of central vision with abrupt onset involving otherwise healthy young males (onset usually around the age of 20).
Three primary point mutations (position 11778, 3460 and 14484) or a mixed cohesistence of secondary mutations in the mitochondrial DNA (mtDNA) of these patients are responsible in 90% of cases for a selective apoptotic death of the papillo-macular bundle fibers; when the loading of damaged mitochondria is over threshold, with impairment of intraxonal ATP production and ROS accumulation, the crisis begins and the patient becomes suddenly symptomatic. LHON is a mitochondrial transmitted disease (from unaffected mother to male offspring) and, despite mtDNA mutations are present in most of the tissues of the affected people, the papillo-macular bundle fibers are the only which are unable to compensate the energy impairment production. Thus, optic nerve is selectively damaged in this disease (blindness and subclinical alterations in the myocardial transmission are documented and MS has been described in rare cases of LHON plus).
LHON in the acute phase: abrupt onset of bilateral painless central visual loss characterized by optic disc pseudoedema and capillary teleangectasia on funuds examination. OCT scanning reveals a thickening of the RNFL layer in the papillo-macular bundle. Visual field examination shows a bilateral scotoma in the central 10° area (Figure 11).
LHON in the chronic phase: 3 to 6 months after the onset of symptoms we can observe an optic atrophy of the papillo-macular bundle as clearly demonstrated on funduscopy and OCT examination (Figure 12).
LHON recovery: partial recovery of vision is reported in the long term of these patients. 11778 point mutations is described as the one with the worse visual prognosis. Unfortunately, vision is severely affected in LHON and patients are legally blind during their future life (Figure 13). Differential diagnosis with toxic-nutritional or other bilateral non inflammatory forms of optic neuropathy is made by clinical course and is confirmed by the presence of mtDNA puntiform mutations on peripheral lymphocytes samples7
Therapy: the only approved treatment for LHON is Idebenone high dose supplementation. Gene therapy is actually under investigation but the first trials have not achieved the expected results.
This is the most common form of hereditary optic neruopathy which is transmitted as an autosomal dominant trait; there is an elevated variability intra- and interpersonal in the phenotype and the clinical landmark is represented by a funduscopic evidence of an atrophic and pale optic disc without cupping. As visual function is maintened to good level of visual acuity up to 60 years, the disease is quite often suspected during a routinary visit in a young children (for example, during screening examination performed to prevent ambliopia). Visual acuity is generally maintened at a 20/40 level with mild dyschromatopsia and photophobia


without nystagmus. Visual field examination will show a bilateral arcuate or cecocentral scotoma with sparing of the periphery. OCT scanning of the optic nerve head will magnify what observed on funduscopy with different degree of aspecific fiber loss involving mainly the papillomacular bundle (Figure 14).
DOA is caused by NUCLEAR DNA mutations in chromosome 3 (region q28-q29) coding for the OPA1 protein which is crucial to maintain an appropriate cytoarchitecture of the inner mitochondrial membrane. An altereted production of this protein will produce a mitochondrial activity impairment with optic nerve atrophy which is typically slowly progressive, bilateral, painless and isolated. Relatives of the proband, when examined, will show variable degree of optic nerve atrophy and variable level of reduced visual acuity.

Prognosis and therapy: Visual acuity is moderately affected and maintained to good level up to 60 years of age and, to date, oral administration of Idebenone is the only treatment that can be recommended to these patients8
Patients with CON may present a painless progressive loss of vision (BCVA, Visual Field and


color vision deficiency) with a RAPD (in monolateral cases). CON is related to primary or secondary optic nerve compression at the intraorbital-intracanalicular level resulting in ipsilateral optic disc edema in the early stages of the compression followed by non-glacomatous optic atrophy in long standing cases, as demonstrated by funduscopy and OCT evaluation. Optociliary shunts vessels are typical in optic nerve meningioma whereas proptosis, chemosis and conjunctival injection are typical for an intraorbital slow expanding mass which may have a neoplastic but also an infective, vascular or thyroid associated etiology (Figure 15)9 In some cases CON may overlap some clinical features with ON (for example may be steroid responsive); for this reason we strongly suggest steroids therapy in ON after that neuroimaging has been performed.
TIMING is crucial for vision of these patients: after appropriate and prompt neuroimaging, the evidence or not of an optic atrophy is the milestone when discussed about visual prognosis of each single case. If optic atrophy is clearly evident, the visual prognosis will be negative even after my treatments options.
Therapy will be related to the causative disorder responsible for CON. As management of these patients is generally very problematic, treatment options must be tailored and must be performed by a well trained multidisciplinary team.
Patients with infiltrative optic neuropathy may overlap clinical features with primary CON with a typical steroid-responsive or steroid-dependent clinical course. Orbital neuroimaging will demonstrate an enlarged optic nerve with inner enhancement. Patient must be evaluated for infectious, inflammatory, neoplastic or toxic etiologies. An appropriate serological evaluation will be carried out according to each patient medical history and examination findings with lumbar puncture and chest scanning often included in the work-up. Haematological malignancies may be frequently responsible for infiltrative optic neuropathy10
This is supposed to be a ischemic small vessel occlusive disease which can be responsible for an irreversible and sever visual loss occurring 18 to 36 months after radiation therapy to the brain or orbit. About three-fourths of cases may be bilateral secondary to chiasmal irra-


diation. The visual loss may be acute and progressive over a 4 to 6 weeks period, resulting in NLP in 45% of patients. In some cases, fundus examination may show optic disc edema with arteriolar narrowing, exudates, hemorraghes, cotton-wool spots, thus resembling a diabetic exudative retinopathy (Figure 16).
Many factors may increase the risk of radiation optic neuropathy: associetd chemotherapy, increased age, and radioation dosage. Radiation doses thought to cause optic nerve post-irradiation damage has been demonstrated to be a cumulative dosage of 60Gy or a fractioned 1.8Gy repetitive dosage. Stereotactic radiosurgery may cause optic nerve and retinal damage when dosage is hjgher than 8-10 Gy.
MRI will demonstrate a diffuse enhancement of both anterior and posterior visual pathway. Unfortunately, despite many different treatments have been proposed in such cases (anti-VEGF antibodies, pentoxifylline or Vit. E supplementation, hyperbaric oxygen therapy) none of them have demonstrated a clear efficacy in restoring patient’s vision.
Bilateral optic nerve swelling secondary to intracranial hypertension. An elevated CSF pressure may be caused by an obstructive mechanism (neoplasm, 70-75% of cases), by a reduced rate of reabsorption (intracranial thrombosis 5-10%, Pseudotumor Cerebri 5%), or by an increased production (meningitis-3%). The increased CSF pressure will spread up to the retrolaminar portion typical of both optic nerves thus producing an axonal and venous stasis responsible for the alterations that can be observed on funduscopy during the acute phase11 .
Bilateral blurred vision, transient visual obscuration, binocular horizontal incomitant diplopia are the common ocular symptoms reported by the patients. Postural changes headache, acuphenes, dizziness and unexpleined vomiting are usually the associated symptoms during the acute phase of the disease.
We can summarize 4 phases of papilledema with typical bilateral alterations of the optic nerve head that can be observed during funduscopy (Figure 17):
1) the initial phase where the optic disc cupping is absent and papillary edema with dilated and congested veins can be observed;
2) the acute/subacute phase with an elevated optic disc, a severe optic disc edema with
marked venous congestion, flame hemorraghes, peripapillary exudates and adjacent retino-choroidal folds;
3) the chronic phase where gliosis of the optic nerve head is the typical landmark toghether with optociliary shunts. A partial or total reabsorption of the hemorraghes and of the exudates can be observed;
4) the atrophic final phase where a progressive flattening and whitening of the papilla is observed with narrowing of the vessels.
BCVA is maintained at 20/20 level until the late stages of the disease: OCT and visual field alterations are peripheral in the early stages with a circular/anular progression in the late stages of the disease (Figure 18).
Management: Patients with an unexplained intracranial hypertension must be hospitalized until the cause of the hypertension has not been demonstrated. Appropriate neuroimaging (cerebral and spinal cord included) must be performed to demostrate the causative origin of the CSF high pressure as soon as possible.
Prognosis: depending from the etiology of the intracranial hypertension, usually high rate of neurological morbities may be suffered from these patients in the long term. The only predictor for a worse visual prognosis is the evidence of an optic atrophy on funduscopic or OCT evaluation of the patient.
Therapy: Cause related. Ophthalmologists must be familiar with Idiophatic Intracranial Hypertension (PseudoTumor Cerebri) as the incidence of the disease is significantly increasing (see specialized book on this topic).
Chiasmatic
Diseases of the optic chiasm may be divided into primary affections due to local or systemic diseases (gliomas or demyelinating lesions) and secondary affections in which the chiasm is involved by pathological processes of adjacent endocranial structures (pituitary gland, tubercle sellae, hypothalamus, circle of Willis, cavernous sinus).
Compression lesions represent the most frequent cause of chiasmatic syndrome (50-70%). Among tumors of the sellar region, the most frequent are pituitary macroadenomas (70%), followed by craniopharyngiomas (20%), meningiomas (5%), and primary gliomas (3%). More rarely causes (2%) may be macroaneurysms of suprasellar arterial vessels of the anterior contingent of the polygon of Willis or compressions starting from the sphenoidal sinus (infectious-infiltrative diseases, sarcoidosis, or nasopharyngeal carcinoma.
Demyelinating diseases account for 10% of primary optic chiasm disorders. Rare causes of chiasmatic disorders are post-traumatic lesions in fractures of the basicranium, collagen diseases, and the clinical setting of empty sella which is the herniation of subarachnoid diverticula in the sella turcica with possible traction and distortion of the chiasm. Symptoms are initially vague and variable depending on whether the chiasm is affected by primary or secondary diseases; in the latter case the ophthalmological symptoms may not be isolated. Patients’ complaint of visual blurring with mono- or bilateral visual acuity reduction. The decrease in visual acuity is of variable magnitude and is not associated with periocular pain. In median compressions, visual acuity is maintained until a distortion of the chiasm is caused by the expanding mass. In the early stage the ophthalmoscopic examination is negative without RAPD, whereas an optic atrophy will be documented on the late stages by OCT scan.
The visual field examination is characterized by temporal alterations in each eye, progressing to the typical defect which is represented by bitemporal hemianopsia. The patient comes to observation reporting bumping into door jambs or because he can’t see people crossing


the street. In 15% of cases, the first symptom of chiasmatic pathology is binocular diplopia secondary to paralysis of the III, IV, or VI cranial nerve due to invasion of the cavernous sinus. In 5% of cases patients any complain of anterior cephalalgia caused by a stretching of the sellar diaphragm. Acute anterior cephalalgia is always present in cases of pituitary apoplexy, which consist of rapid expansions by hemorrhagic necrosis of pituitary macroadenomas whit

acute intracranial hypertension secondary to a block in the CSF circulation (Figure 20). Apoplexy may represent a neurosurgical emergency so an acute, severe recent headache is always a symptom that should alert the physician. Although the first cause of chiasmatic disease is pituitary macroadenomas, endocrine dysfunction and its related symptoms are reported only late by the patient, especially in cases of male impotence.
Treatment is secondary to the etiology of the chiasmatic syndrome. Treatment can be hormonal, radiotherapic or surgical depending form a multidisciplinary decision of the multidisciplinary team which is managing the patient12 .
Retrochiasmatic diseases are mainly ischemic or compressive with clear predominance of vascular accidents. More rarely, injuries are infective (occipital abscesses), traumatic, or infiltrative.
Most ischemic lesions of the posterior optic pathways are isolated and have no associated neurologic symptomatology. They are a symptom of cardiovascular disease that must be investigated and treated at that level.
Visual acuity initially is not reduced and visual impairment consists of large scotomas affecting the visual field characterized by the fact that they affect the same areas of the visual field in both eyes (homonymia) which can is complete when represented by homonymous hemianopsia. Pupillary reactions and fundus examination are in the normal range in post geniculate optical radiation lesions. The damage is post-synaptic, so there is never optic atrophy in the early stages of the disease.
A homonymous hemianopsia is a suspicion of optic tract involvement when is incongruous and patient complain of reduced VA. Optic atrophy is easily detectable by both ophthalmoscopic examination and OCT scan.
An isolated lesion of the lateral geniculate body is extremely rare because it falls within ischemic lesions of adjacent nerve structures. Ocular symptomatology is always associated with major neurological deficits. Those lesions are associated with incongruous cone-shaped homonymous alterations on visual field examination.
Temporal lobe lesions usually present with homonymous hemianopsia associated with neurologic disturbances such as hemiplegia due to proximity to the internal capsule, hemianes-
thesia, aphasia if the dominant hemisphere is affected, agnosia, and visual, auditory, olfactory, and gustatory hallucinations.
The fibers run closer together as they proceed from the lateral geniculate body toward the calcarine scissure.
Lesions of the parietal lobe usually produce congruous deficits than temporal lesions affecting the contralateral inferior homonymous quadrants and may widen superiorly to give complete hemianopsia if the brain lesion is extensive. Associated neurological deficits are hemiplegia, severe hemianesthesia, alexia, and asomatognosia. They are usually so severe as to make visual field testing untraceable. In some cases, tonic deviation of the eyes toward the side opposite the lesion can be observed, with abolition or attenuation of optokinetic nystagmus by turning the stimulus toward the injured side. The causes of injury at this level are usually neoplastic, ischemic, or infectious. Visual acuity is maintained at 20/20 level, pupillary reactions and fundus examination are normal.
Occipital lesions are characterized by a homonymous and congruous visual field defect (Figure 21). Visual cortex predominantly occupies the medial portion of the occipital lobe. The macula on each side has dual representation on both lobes. Peripheral visual field has the anterior projection on the interhemispheric scissure, while the macula the macula has a more posterior projection to the end of the lobe.
The phenomenon of macular sparing is often observed for the double macular representation. Macular sparing is the preservation of the central 5-10° on the side of the amianopsia. Furthermore, a state-kinetic dissociation can be observed (Riddoch phenomenon), that is, the perception of movement but not the shape of an object. This phenomenon is not exclusive to occipital lesions and is probably caused by alterations in the associative visual areas (V2 and V1). The visual acuity of these patients is maintained, pupillary reactions and fundus examination are normal.

Most frequently reported symptoms are headache, nausea and vomiting. Area V1 has connections with other secondary associative areas, so pathologies affecting these districts may give complex neurophthalmological clinical pictures. Right homonymous hemianopsia with alexia without agraphia is typical of a usually ischemic lesion of the left cortex extending to the posterior commissure. This lesion results in a true disconnection: visual information from the right V1 area (not involved in the stroke) cannot reach the associative areas of language located in the left temporal and parietal lobes. Patient has alexia without agraphia because the latter signal follows other pathways that bypass the splenium of the corpus callosum. Bilateral retrogenicular optic pathway lesions result in cortical blindness with complete deficit of visual function, while fundus oculi, pupillary reflexes, and extrinsic ocular motility are normal. Visual hallucinations are frequent in these subjects. Higher cortical lesions at the level of connection bundles and visual associative areas can also result in visual agnosia, a disorder in which patients report seeing objects or people but without recognizing them (I can see but I can’t recognize).
Anisocoria
Anisocoria is the difference of at least 0.5 mm between the diameter of the two pupils. Anisocoria may be caused by diseases that can bring an alert patient to death in few hours or days. For this reason, when evaluating a patient presenting with an acute anisocoria, physicians must be aware that patient these kinds of patients MUST BE CONSIDERED AS A REAL NEUROPHTHALMOLOGICAL EMERGENCY until otherwise proven. Acute painful miosis and acute painful mydriasis need a work-up of the patient in the emergency department as both may be the first clinical manifestation of life-threating disorders (mainly vascular/neurological). When approaching a patient with pupillary abnormalities, we have to investigate the reaction to light and near vision, the difference of anisocoria in light and dark, as well as possible abnormalities in pupil size and shape: we have also to investigate if there is any evidence for pharmacological pupillary abnormalities, the onset of the problem and if the alteration is intermittent or not.
When discussing of “neurologycal anisocoria”, we have to rule out first any structural iris alterations on slit-lamp examination (post cataract surgery, posterior synechiae, iris trauma, etc.). When anisocoria is isolated (no associated signs) we have to understand which is the affected side: from a routinary clinical point of view, we can easily detect the pathologic side (when monolateral) by measuring the pupil diameters in a bright illuminated room or in dim light conditions. If anisocoria increases in an highly illuminated room, the pathological side will be the one with mydriasis, whereas if anisocoria decreases in scotopic conditions the affected side will be the one in relative miosis (Figure 22).
In the presence of anisocoria, the first investigation to perform is the examination of the pupillary light reflex. When anisocoria is isolated, equal in light and dark, less than 1 mm., asymptomatic and with a normal reflex for near vision, anisocoria can be physiological (1520% of population).
Miosis can be caused by all the diseases responsible for parasympathetic (spastic) stimulation or sympathetic paralysis (paralytic). This pathogenesis does not include the miosis resulting from eye diseases of non-neurogenic origin, such as posterior irideous synechiae, following iridocyclites.
Spastic myosis is due to the hyperfunction of the parasympathetic, resulting in a pupillary


sphincter spasm. The dark and near pupillary reflexes are abolished. It results from eye diseases, such as iridocyclitis or contusive trauma of the eyeball; in the latter, miosis mostly follows mydriasis. It can also be followed by the instillation of parasympathomimetic drugs that act directly on muscle effectors, with a similar action to acetylcholine (pilocarpine etc.), or blocking acetylcholinesterase (eserine etc.). It is also secondary to the irritation of the Edinger-Westphal nuclei, to the elimination of hypothalamic inhibitory impulses directed to these nuclei or to the irritation of the parasympathetic pupil fibers along the course of the III cranial nerve.
Hemorrhages and tumors of the pons (although it is not clear whether the miosis is caused by the paralysis of the sympathetic pupillary pathways or if both pupillary systems are affected simultaneously) are counted among the conditions that could cause irritation of the Edinger-Westphal nuclei.
Spastic miosis, due to probable reduction or elimination of the hypothalamic inhibitory impulses for the Edinger-Westphal nuclei, resulting in prevalence of pupilloconstrictor tone, is sometimes observed during cerebral arteriosclerosis, in acute alcoholism, in certain stages of coma, fatigue, middle stage anesthesia, after the administration of opiates (heroin, morphine), or diabetes mellitus. The diseases that can cause irritation of the parasympathetic pupil fibers along the course of the III cranial nerve are meningitis of the base, especially tubercular and luetic, the thrombophlebitis of the cavernous sinus and the orbital flogous with involvement of the ciliary ganglion.
Paralytic miosis (Horner’s syndrome) follows the paralysis of the sympathetic pupillary nerve for the dilatator muscle, thus prevailing the sphincter action. It is characterized by miosis and ptosis, which may be associated with enophthalmos, hemifacial anhidrosis or vasodilation homolateral to the lesion (Figure 23).
Paralytic miosis, unlike spasticity, is never very pronounced; photomotor reflex and near pupillary light reflex are preserved or attenuated. The eye drops test is particularly useful because, if performed correctly, it allows to distinguish paralytic miosis from spastic and preganglial lesions from postganglionic ones.
Paralytic miosis (Horner’s syndrome) is characterized by miosis and ptosis, which may be associated with enophthalmos, hemifacial anhidrosis or vasodilation homolateral to the lesion.
Paralytic miosis, unlike spasticity, is never very pronounced; photomotor reflex and near pupillary light reflex are preserved or attenuated. The eye drops test is particularly useful because, if performed correctly, it allows to distinguish paralytic miosis from spastic and preganglial lesions from postganglionic ones13
The sympathetic pupillary pathway is a very long three-neuron chain that can be damaged along its course from the hypothalamus to the orbital ciliary ganglion. HS may be caused from many pathologies located at different anatomical level which may be difficult to identify.
Horner’s syndrome in hypothalamic, thalamic, brainstem and spinal cord disorders
Horner’s syndrome (HS) can occur in hypothalamic and thalamic diseases, among which mostly hemorrhages: lenticular capsular ones are the most frequent, followed by the supratentorial bleedings. In case of hypothalamic injury, especially posterior and ventrolateral, coma and homolateral HS characterized by anhidrosis extending to the whole half of the body (and not only to the face and neck) can happen, as well as in more caudal lesions. Horner’s syndrome, which sometimes occurs during the occlusion of the internal carotid artery, is likely to result from hypothalamic damage. Thalamic hemorrhages cause loss of consciousness, often short-lived, mostly transient contralateral hemiplegia, sensory disturbances (hypoesthesia or anesthesia), Horner’s syndrome and sometimes paralysis of vertical eye movements.
As regards the brainstem diseases, HS shows itself in the course of vascular ischemic accidents (encephalomalacia). At the peduncular level these are caused by the occlusion of the cerebellar artery branches and HS occurs on the side of the lesion; paralysis of the IV cranial nerve and contralateral sensory and pain perception are present as well. At bulbar level, the softening most frequently follows ischemia in the territory of the pit artery, branch of the vertebral or cerebellar inferior posterior artery.
Siringomielia is the most frequent among the cervical medulla diseases in which Horner’s syndrome is present.
Other spinal cord disorders in which HS may appear, obviously in association with other neurological symptoms, include spinal cord injury, demyelinating diseases, polio, spinal cord compressions following trauma or Pott’s disease.
Horner’s syndrome concomitant with injuries of the thoracic and neck nerves
At the I-II dorsal segment, the sympathetic pupillary fibers emerge from the spinal cord following the anterior roots of the thoracic nerves through the intervertebral holes. At this level, Horner’s syndrome is associated with both primitive spinal nerve disorders such as neurofibromas, vertebral disorders and hypertrophic arthritis with narrowing of the intervertebral holes.
The anterior root of the I thoracic nerve, which is located outside the vertebral canal, becomes part of the brachial plexus, also composed by the corresponding roots of the last four cervical nerves. The most frequent causes of injuries to the brachial plexus are traumas, especially those resulting from violent traction of the arms on the head as happens in obstetrics. Horner’s syndrome can also occur during aneurysms of the ascending aorta, of the subclavian and of the common carotid artery which cause mostly severe neck pain, difference in blood pressure between the two arms and displacement of the trachea.
Horner’s syndrome can also arise in mediastinal pathologies, such as lymphogranuloma or leukemia.
When the cervical ganglion is affected in the tract between the intermediate ganglion and the upper cervical one, thyroid neoplasms, laterocervical lymphoadenitis, trauma, neurinomas of the sympathetic chain, retropharyngeal neoplasms or aneurysms of the branches of the carotid artery must be sought; in these cases Horner’s syndrome is obviously associated with different symptoms.
Finally, Horner’s syndrome can follow the surgery of mediastinum or neck purposely aimed at a disruption of the sympathetic chain or those types of surgery in which this phenomenon is inevitable or accidental as for carotid angiography, or during the attempt to internal jugular vein cannulation and, sometimes, the stellate ganglion block resulting from infiltration capable of eliminating a painful symptomatology. In addition, this syndrome may show up because of radiant treatment after surgery.
Horner’s syndrome due to lesions of the superior cervical ganglia, carotid and and cavernous plexus
The superior cervical ganglia may be affected by neoplasms of the nasopharynx, in which Horner‘s syndrome is associated with dysphagia, tongue paralysis and anesthesia of the pharynx. In the carotid canal, pupillary fibres may be damaged during pyogenic otitis media. Once reached the skull, the sympathetic fibres can be damaged by fractures of the base, syphilitic osteitis, alcoholization of the trigeminal ganglion and sometimes herpes zoster infection. Horner‘s syndrome can occur during facial vascular pain or also during headache. During spontaneous or traumatic dissection of the internal carotid artery, monolateral Horner’s syndrome can represent one of the initial symptoms. The diagnosis is made by means of cerebral angiography and magnetic resonance angiography, which reveal a diffuse narrowing of the artery from the carotid bifurcation to the cranial base. Actually, drop testing with 4-10% cocaine and 1% hydroxyamphetamine in HS is not any longer utilized in favour of MRA of the brain and the neck up to the apex of the lungs.
Pathological mydriasis may secondary to a spasm of the pupillary dilatator muscle or to a paralysis of the parasympathetic pathway with loss of the constrictor muscle activity. Congenital mydriasis is an extremely rare condition usually secondary to aplasia of the iris.
In spastic mydriasis the diameter of the pupil is generally around 5 mm. under photopic conditions and the pupil reacts slowly to light and accommodation. This condition has been reported in several mental diseases (see for example in schizophrenia) and is thought to be related to sympathetic activation with an increase of hypothalamic inhibitory impulses on the Edinger-Westphal nuclei (these mechanisms are responsible for emotional mydriasis under normal conditions).
Paralytic mydriasis occurs in concomitance with the parasympathetic pupillary paralysis as the tone of the pupillary sphincter is absent, and the dilator tone, innervated by the sympathetic nerve, is dominant. The paralytic form causes a very accentuated mydriasis, with total abolition of the pupillary reflexes (photomotor, near pupillary reflex etc.), while the pupil responds to the instillation of myotics. It is almost always associated with paralysis of accommodation, so near vision is clouded, and often is associated with a total or partial III nerve palsy involving its extrinsic muscular component (ptosis and exotropia). It results in ocular pathologies (contusive trauma, acute glaucoma), instillation of parasympatholytic drugs such

24. Right partial third nerve palsy with pupillary involvement in dilating aneurysm of the posetior cerebral artery

as atropine or scopolamine into the conjunctival sac, lesions of the Edinger-Westphal nuclei or of the parasympathetic pupillary fibers of the III cranial nerve. Edinger-Westphal nucleus lesions recognize vascular, neoplastic or demyelinating origins. At nuclear level, the paralysis of the III intrinsic cranial nerve (resulting in mydriasis and paralysis of accommodation-internal ophthalmoplegia), is isolated when an occlusion of the fine arterial branches from the posterior cerebral artery is established, being the vascularization of somatic nuclei of the III cranial nerve separated.
In the case of pupillary fibers damage in the root tract of the III cranial nerve (between the Edinger-Westphal nucleus and the emergence from the brainstem), the pupillary disorders are associated with complete nerve paralysis and fall into the alternate syndromes of the brainstem (Nathnagel, Benedikt, Weber sdr.) mostly vascular etiopathogenesis where the hemiparetic contralateral neurological symptoms are dominant.
Related to its anatomical relationships at the troncular level, a complete (or partial BUT with pupillary involvement), painful and acute III nerve palsy may be the first and isolated manifestation of a dilating aneurysm of the posterior communicating or of the upper cerebellar arteries (Figure 25). This is a real neurophthalmological life-treating emergency. In this clnical setting, patient must be aggressively investigated until otherwise proven.
Argyll-Robertson’s Pupil
This disorder consists of a light-near dissociation of the pupillary reflex; there is an absence of the pupillary light reflex in front of a normal with near vision reflex. It is usually bilateral, more rarely unilateral. The pupil is myotic, mostly oval along the vertical or horizontal meridian; iris atrophy is often observed at slit-lamp examination. The most frequent cause of AR pupil is neurosyphilis occurring in almost 50% of progressive cases. This patient may have psychiatric progressive dementia and neurological (dysarthria, tremor, especially of the lips and lingual region) pathologies. In tabes, the Argyll-Robertson’s pupil is frequent and is associated with sudden and lightning pains, visceral crises, sensory disorders, hypotonia, areflexia, neurotrophic disorders, sphincter and genital disorders. In addition to the neurosyphilis, the A-R pupil is described in diabetes mellitus, multiple sclerosis, cerebral arteriosclerosis, mesencephalic neoplasms, chronic alcoholism, pinealomas. In some of these conditions this pupillary disorder is part of the dorsal midbrain syndrome. The anatomical site of lesion, in the Argyll-Robertson’s pupil, is located in the midbrain dorsal-rostral portion, around the aqueduct of Sylvius. An injury in this area would cause the disruption of pretectal direct and cross-linked fibers, especially those leading the inhibitory impulses from the hypothalamus to the Edinger-Westphal nuclei. The near vision pupillary
reflex is arguably conserved because the fibers responsible for it run in the ventral portion of the midbrain, which would be spared from the injury.
Adie tonic pupil (Holmes-Adie’ syndrome)
It consists in an overall reduction of the pupillary reflexes. The pupil is usually mild dilated, the light reflex is apparently absent but it can be evoked by exposing the subject for a prolonged time to a very intense light. Pupil shrinking is very slow as for the near vision and back to far vision again. Tonic pupil is usually monolateral (90% of cases).
These pupillary disorders may be associated with a reduction, abolition or asymmetry of the tendinous reflexes especially for the patellar and Achilleous one (H-A Syndrome). The disease is benign, affects mainly female between 20 and 40 years old, with a sneaky onset often reported as blurring during near vision from the patient14
The etiology is mostly unknown and the disease occurs in otherwise healthy subjects; sometimes it has been described in orbital sarcoidosis, temporal arteritis, after surgery for retinal detachment, in ophthalmic herpes zoster or chickenpox, after retrobulbar alcohol injections, in orbital traumas, in orbital or choroid tumors, after extended argon-laser photocoagulation or after extensive cryotherapy of the retina and choroid.
The benign nature of this disease (orbital ganglion cells peripheral lesions) can be confirmed observing an evident miosis secondary to the instillation of 0.125% diluted pilocarpine (denervation hypersensitivity).
Changes in the pupils are extremely useful for diagnostic and prognostic purposes during coma. They are very helpful in orienting on the location of the lesion (when it involves diencephalon, mesencephalon, or pons), on the type of coma (due to metabolic diseases, toxic states or rather to localized supra or subtentorial cerebral lesions); and finally on the prognosis. Fixed bilateral mydriasis lasting for few minutes is a worse prognostic sign as it generally denotes irreversible brain lesions.
Correlations between coma and pupillary disorders are explained by the close relationships existing between the sympathetic and parasympathetic pupillary pathways which originate in the hypothalamus and in the brainstem- with the ascending reticular activating system whose damage is responsible for coma. The most frequent cause of paralytic mydriasis in severe brain trauma in a comatose patient may be related to the herniation of the temporal uncus in the foramen ovale resulting from supratentorial masses. The pupil disorders are usually the first symptom and consist initially of unilateral fixed mydriasis followed by paralysis of the III cranial extrinsic nerve, homolateral hemiplegia and sensory disturbances that can reach to coma. Mydriasis may initially be intermittent; it is mostly, but not necessarily, homolateral to the lesion and is thought to be caused by compression of the III cranial nerve against the edge of the cerebellar tentorium, or, more rarely, against the cerebellar superior. The insertion of the temporal uncus in the oval foramen may be due to a particular tumor, such as occipital, temporal or frontal lobe, cerebral abscesses or extra- or subdural hematomas. In the acute forms of the latter, pupillary disorders are present in more than 60% of cases, against 10% of chronic forms; mydriasis is also present mostly in the same side of the hematoma15
SUPERNUCLEAR disorders of gaze are due to lesions located along the cortical and subcortical nerve pathways involved in oculomotion. Lesions in superior cortical areas produce different S&S compared to lesions occurring at NUCLEAR, INTERNUCLEAR, or INFRANUCLEAR level; the
clinical presentation of these conditions is very different even in terms of causes, prognosis and treatment.
SUPRANUCLEAR anatomical structures “project” and coordinate the action of the extraocular muscles by controlling basically two types of eye movements: the CONJUGATE eye movements (also called ocular versions, in which the two eyes move simultaneously in the space in the same direction) and the DISJUNCITVE eye movements (convergence and divergence) in which the two eyes move in opposite directions. Conjugate movements are further divided into two subgroups: the SLOW TRACKING eye movements (continuous neural circuit with low but constant discharge frequency) and the fast ones (called SACCADIC EYE MOVEMENTS which are ruled by a discontinuous neural circuit); both of them can be activated by visual and nonvisual stimuli and may be voluntary or involuntary.
We can summarize the actions of oculomotion in four essential tasks: 1) keep the gaze “stable” on an object that is being looked at; 2) the visual exploration of the surrounding space; 3) follow a moving object and 4) maintain a binocular alignment.
To accomplish these tasks, at least six 3D eye movement control systems exist. They are provided with a retinal feedback system (foveal angular displacement of the object resulting in displacement of the eyes) and a “Feed-Forward” system that stabilizes images by moving the eyes through extra-kinetic inputs such as the vestibular ones.
The horizontal versions originate in the nucleus of the 6° cranial nerve (abducens nerve) of each side; among the four subtypes of motor neurons that are found here, the internuclear neurons reach the contralateral subnucleum of 3° cranial nerve through the Medial Longitudinal Fasciculus (FLM), so that it activates the medial rectus muscle. This circuit receives afferent fibers from the vestibular system, from the Paramedian Pontine Reticular Formation (PPRF), and from the cerebellum (flocculus, VI and VII lobes of the cerebellar vermis). The cortical projections for PPRF are mainly from the prefrontal cortex (Frontal Eye Fields) and the parieto-occipital cortex.
The supranuclear center is located in the Reticular Formation of the whole brainstem: over there, the nerve impulses for vertical gaze movements are modulated and integrated, since these movements require a more complex integration than the horizontal ones (activation of four muscles compared to the two necessary for horizontal eye movements, which are innervated by motor neurons of the 3rd and 4th cranial nerve homolaterally). The premotor nucleus is represented by the interstitial rotor FLM (riFLM), located dorsally to the red nucleus, laterally to the Darkschewitsch nucleus and above the Cajal nucleus. It is likely that the nerve impulses for vertical and torsional movements originate in the medial portion of the PPRF which projects directly to the rostral interstitial nucleus of Cajal of the FLM and receive input from the vestibular system; in this nucleus, upward movements could originate from dorsal neurons, whereas downward movements would originate from ventral neurons. The supranuclear projections for vertical versions converge both in the PRETECTUM region as well as in the dorsal portion of the brain corresponding to the superior collicula. Mesencephalic reticular formation receives projections from cortical areas such as the frontal area 8, the parietal-occipital area and the basal ganglia. The course of the projections from these areas is unknown but probably it is the same as for horizontal movements, with the fibers converging at the mesencephalic dorsal level (bilateral fronto-mesencephalic projection in the pretectal area).
We should also remember that the eye movements have at least 6 control systems (whose details can be studied in specialized texts):
1) Oculo-vestibular reflex
2) Opto-kinetic reflex
3) Fixational eye micromovements
4) Saccadic movements
5) Slow tracking movements
6) System of vergences
Horizontal disorders of gaze
Horizontal paralysis of the eye due to the injury of the brainstem can be described as Foville syndrome (inferior pontine syndrome). The etiology is variable: thrombosis of the basilar trunk, pontine hemorrhage, pons glioma, cerebellar neoplasia, tumor of the pontocerebellar angle (especially neurinoma of the acoustic nerve), multiple sclerosis. The horizontal paralysis of the eye is ipsilateral to the lesion; therefore, the eyes are divergent, due to the prevailing tone of the antagonistic eye muscles, towards the healthy side. Paralysis of the VI and VII nerve on the same side of the lesion concomitant with contralateral hemiplegia.
Horizontal eye paralysis can also occur due to subcortical or cortical lesions: the former include the affections of the central grey nuclei (caudate nucleus, putamen, globus pallidus) which play a fundamental role in the control of motility. The etiology includes: large capsular-lenticular hemorrhage, basal ganglia neoplasms, Huntington’s chorea, multiple sclerosis, spinocerebellar degeneration and congenital oculomotor apraxia. Cortical lesions that cause horizontal eye paralysis mostly result from single-sided occlusive stroke of the arteries in the frontal eye field, mainly originating from the middle cerebral artery, from the Wernicke-syndromeKorsakoff’s syndrome, or from bilateral hemispherical lesions with the involvement of the frontal lobes16
In subcortical or cortical lesions, horizontal paralysis of the eye is contralateral to the site of the lesion. Therefore the gaze is divergent to the same side of the lesion, because of the dominating tone of the antagonistic oculomotor muscles. This is explained by the break in the fronto-mesencephalian fibres above their crossing. The fronto-mesencephalic fibres originate, in each hemisphere, from Brodmann area 8 (frontal eye field), collect in the knee of the internal capsule, sending a first large group of projections to the striatum, thalamus and subthalamus, the upper colliculus, the pretectal region and mesencephalic reticular formation. In the latter, the main beam of fibers from area 8 penetrates into the rostral (fronto-mesencephalic encephalic system) mesencephalon and, following it to its caudal portion, crosses the median line in the rostral portion of the pons and ends in the controlateral paramedian brainstem reticular formation (horizontal gaze center, of whom one center for each side is present).
Horizontal changes in the gaze due to irritative lesions are manifested by spastic deviation of the horizontal gaze to the opposite side of the lesion. They are mostly caused by epilepsy crises in the course of frontal neoplasms.
Mesencephalic lesions, when affecting the rostral part of the midbrain, cause the the sylvian aqueduct syndrome (or Parinaud’s syndrome) characterized by a complete vertical paralysis of the eyes, rotatory and mostly rhythmic nystagmus of the convergence in the attempts of
look upwards, mydriasis, absence of pupillary light reflex with miosis in convergence. Parinaud’s syndrome mainly appears in the course of neoplasms, especially pinealoma, hydrocephalus or vascular diseases. The neoplasm that most frequently causes Parinaud’s syndrome is pinealoma in male adolescents; symptoms gradually arise with blurring of distant vision, accommodation difficulties and transient episodes of vertical diplopia. Whenever the patient begins a saccade upward, his eyes first converge and then diverge. The Bell’s phenomenon, that is the elevation of the eyes during the force closing of the eyelids, is mostly absent. In the course of pinealoma, there may also be papillary stasis due to the intracranial hypertension and paralysis of the III or VI cranial nerve17. Huntington’s disease, Wilson’s disease, parkinsonism, congenital athetosis and Sydenhan’s chorea can result in subcortical and/or cortical lesions thus causing vertical paralysis of the eye. The irritative lesions that cause vertical alterations of the eye occur in the form of ocular crises such as postencephalitic parkinsonism or as an acute effect of therapy with neuroleptic drugs.
It is a horizontal eye disorder and consists inability to adduct one eye with horizontal nystagmus of the controlatreral eye. The function of the internal rectus muscle is mostly preserved during convergence. It arises from the unilateral lesion of the FLM in the pons. In young adults the most frequent cause is multiple sclerosis; in elderly people, vertebrobasilar vascular diseases are prevalent. Other causes are brainstem cancer, encephalitis, Hodgkin’s disease, alcoholism, and Arnold-Chiari malformation. When INO is bilateral, we can observe the “one and a half” syndrome18
Nystagmus consists of a rhythmic and involuntary oscillation of the eyes; it is mostly binocular, rarely monocular19. The eye oscillations can be performed on the horizontal, vertical or rotatory plane and may be pendular or jerky; in the former case the eye oscillations are of equal speed in both directions. In the case of nystagmus, the initial phase is slow, followed by a rapid phase in the opposite direction. The slow phase represents a pathological movement, while the fast phase is corrective. By convention, this type of nystagmus is determined according to the direction of the rapid phase. If, for example, this one is directed to the right, nystagmus occurs in the same direction. When it is carried out in the anteroposterior plane, nystagmus is of a rotary (or torsional) type. In this case its trajectory has a fast phase that is clockwise or counterclockwise, with respect to the observer and not to the patient. Two types of nystagmus are distinguished: physiological and pathological.
Physiological nystagmus is evoked by a rapid rotation of the head, by the instillation of hot or cold water in the ear canal (vestibular nystagmus) or by the observation of a rotating cylinder with black and white stripes (optokinetic nystagmus). The labyrinthine and visual stimulation, although occurring through different neural archs, end up in the neural center located in the reticular formation of the brainstem. Nerve impulses activate ocular movements through the medial longitudinal fasciculus and the nuclei of the oculomotor nerves. This is the common neural pathway for rapid (saccades) and slow movements (horizontal and vertical gaze tracking).
Physiological nystagmus onsets in the extreme positions of the horizontal gaze with the rapid phase directed in the same direction of the gaze, it is symmetrical for both eyes and is never concomitant with other pathologies. A purely vertical nystagmus is always pathological.
Pathological nystagmus generally include persistent nystagmus, in the presence of good vision, and derives from a failure of the brainstem. Pathological nystagmus is distinguished into childhood and acquired nystagmus, respectively.
Nystagmus in childhood may be congenital, latent or included in spasmus nutans syndrome. Congenital nystagmus (or infantile nystagmus syndrome) occurs at birth or within the first three months of life. It can be associated with ocular diseases such as optic nerve hypoplasia, congenital Leber’s amaurosis, oculocutaneous or ocular albinism, cones dystrophy, cataract, corneal opacities, coloboma, aniridia, or premature retinopathy. In the absence of these diseases, nystagmus can be hereditary with autosomal dominant, autosomal recessive or sexlinked transmission. Congenital nystagmus is bilateral, it can be jerky or purely pendular; eye oscillations are symmetrical, as for amplitude and frequency, on the horizontal plane also in the upward gaze. In a certain position of the eye oscillating movements are reduced with the improvement of visual acuity, so that demonstrating that no ocular pathologies are present (null zone). Nystagmus is abolished during sleep.
True latent nystagmus (or fusional maldevelopment nystagmus syndrome) occurs only if an eye is occluded. The presence of strabismus may play an important role in its pathogenesis. In the spasmus nutans (or spasmus nutans syndrome) or nystagmus in the dark, nystagmus can be associated with head tremor and stiff neck. It occurs mostly between the 3rd and 9th month after birth; it is predominantly horizontal, monocular or asymmetric. Nystagmus is present in the primary position of the head. Symptomatology lasts for a few months and up to a few years and resolves around the age of 3-4.
The acquired nystagmus can be pendular or jerky. Acquired pendular nystagmus is rare and arises in concomitance with diseases of the brainstem, in miners or in monocles.
• Disease of the brainstem result from multiple sclerosis, Pelizaeus-Merzbacher disease, peroxisomal disorders, Cockaine syndrome, toluene abuse, vertebrobasilar artery insufficiency or from taking sedatives at toxic doses. This nystagmus causes a nagging oscillopsia.
• Miners’ nystagmus occurs in miners after a long period of work and is caused by poor lighting conditions or the position of the head.
• Pendular nystagmus in monocles can appear in both adult and children, even in functional monocular patients, when the best eye shows a gradual visual decrease. The nystagmus acquired by shocks is the most frequent form of nystagmus and is caused by pathologies of the vestibular pathways and nuclei or can be evoked by some positions of the gaze.
Diseases of the vestibular pathways and nuclei such as labyrinthitis, neuronitis, Menière’s disease, trauma, vascular diseases especially due to the occlusion of the posterior inferior cerebellar artery (Wallenberg syndrome), acoustic neurinoma and multiple sclerosis cause nystagmus. Shocks are most involved in the primary position of the eye.
The nystagmus consequent to shocks can be evoked in the extreme positions of the gaze while it is absent in the primary position. It is manifested during the resolution of horizontal eye paresis, in the course of acoustic neurinomas, cerebellar neoplasms, multiple sclerosis, cervical medullary neoplasm, as a consequence of the use of sedative and convulsive drugs or for alcohol intoxication.
Particular types of nystagmus include periodic alternating nystagmus, seesaw nystagmus, rebound or downbeat, dissociated nystagmus, nystagmus associated to myasthenia and convergent retraction nystagmus.
Nystagmus should not be confused with intrusions and saccadic oscillations (ocular bobbing, ocular myoclonus, opsoclonus, ocular dysmetria, ocular flutter, voluntary nystagmus). Unlike nystagmus eye oscillations, the slow initial phase is not present in these cases. The intrusions and saccadic oscillations are an expression of a cerebellar dysfunction and are associated with neurodegenerative diseases such as progressive supranuclear paralysis, Parkinson’s disease and chorea-acanthocytosis.
Disconjugate (or disjunctive) eye movements are synchronous movements of the two eyes in opposite directions. The rotation of one eye towards the other one is called convergence, and the movement of one eye to the one side and the other one to the opposite side is called divergence.
Convergence occurs by the activation of the two medial rectus muscles with simultaneous inhibition of the lateral rectus: together with accommodation and miosis it constitutes the reflex (or syncinesia) for close-up vision (or the triad for close).
The supranuclear centers regulating vergences are not yet known with certainty. The convergence is in some way involved in Brodmann areas 19 and 22, the medial superior temporal visual area, the frontal eye field and the frontal supplementary eye field. From these cortical areas the convergence impulses would reach the mesencephalic pretectal and tectal areas, by means of a system of bilateral projections coming from the two hemispheres. In these mesencephalic areas, the pupillary fibers and those responsible for vertical movements of the gaze also converge, which explains how the paralysis of convergence for a lesion at this level is associated with alterations of the pupillary and the vertical gaze.
Fibers deputed to the convergence, perhaps through the superior brachial plexus, reach the nuclei of III nerve (responsible for the innervation of the internal rectus muscles) from the tectum and pretectum.
The cortical centers appointed to the divergence could be the same as convergence, while the subcortical center could be located near the VI nuclei on the pons median line.
It causes crossed diplopia when the patient is staring at a nearby object. Diplopia is absent when he looks at distant objects. During the movements of the horizontal gaze, the function of the medial rectus is preserved during adduction, thus denotating the absence of their true paralysis. The paralysis of convergence is mostly associated with absence of accommodation and absence of myosis in near vision, indicating a mesencephalic lesion. The most frequent causes are neoplasms, especially pinealoma, encephalitis, diphtheria, multiple sclerosis and vascular occlusions of the rostral midbrain.
The paralysis of convergence is distinguished from the paralysis of accommodation in which the most annoying subjective symptom is usually micropsia; that is, objects appear smaller for a defective evaluation of distance. It follows the parasympathetic innervation paralysis of the ciliary muscle, provided by III cranial nerve; the paralysis of accommodation is rarely isolated, mostly associated with pupillary paralysis (internal ophthalmoplegia) and total or partial paralysis of the III extrinsic nerve (ptosis, divergent strabismus). The causes of paral-
ysis accommodation are multiple: one of the most frequent is the botulinum intoxication (botulism) after the ingestion of spoiled food. The severity of the intoxication depends on the amount and the type of toxin ingested; botulinum poisoning of type A causes the most severe symptomatological clinical presentations, while B the mildest form (benign or outpatient botulism). In this case, disorders of the autonomic nervous system prevail, and the paresis of accommodation is revealed by the blurring of near vision; together with the dryness of the mouth and eyes it constitutes the most constant symptom of intoxication. The other symptoms are constipation, abdominal cramps, nausea, vomiting, general weakness and orthostatic hypotension. Most symptoms occur after 30-35 hours of food poisoning, and they are preceded by nausea and vomiting.
It causes homonymous diplopia when the patient observes objects located at a distance of more than 30 cm. It can manifest in the course of neoplasms of the posterior skull fossa, especially subdural hematomas, or conditions such as intracranial hypertension.
The symptoms are binocular diplopia, confusion and false location of objects thus producing an eye vertigo. The deviation is accentuated in the field of action of the paralyzed muscle in the acute phase (lasting 3 to 6 months); after this period, if recovery is not occurred, a chronic phase of the paralysis is coming (6 to 12 months). This latter phase is characterized by a concomitant phase in which, due to a prolonged muscle contraction with consequent fibrosis, the angle of strabismus becomes equal in all the positions of gaze. Another clinical sign of paretic strabismus is the presence of an abnormal head position which aims to reduce confusion and diplopia. The head may be rotated, with chin elevation or depression, and tilted on one shoulder. Rotation reduces diplopia by causing a reflex counter-rotation of the eyes and occurs in the field of action of the paralyzed muscle. The head is tilted on a shoulder when a vertical muscle is paralyzed, in order to neutralize its vertical and torsional action. All these abnormal head positions can become chronic, leading to ocular torticollis and sometimes cervical scoliosis.
Paretic strabismus can be either primitively neurogenic or myogenic. Neurogenic paralysis affects the III, IV and VI pair of cranial nerves and this may occur in an isolated form or not. The main causes are represented by vascular diseases, cranial trauma, neoplasms, diabetes mellitus, multiple sclerosis, inflammation sustained by viral or bacterial agents; their etiology is sometimes presumed or even impossible to determine.
Myogenic paralysis includes the palsy of oculomotor muscles caused by primitively myogenic conditions such are myasthenia gravis, progressive external ophthalmoplegia, dysthyroid myopathy and orbital myositis20
The clinical features of paralyzed oculomotor nerves vary according to the site of the lesion and are divided into nuclear, fascicular, radicular or trunk palsies.
Nuclear palsy of the third pair of cranial nerves are bilateral with more or less symmetrical involvement of the muscles in both eyes, often with savings of the intrinsic ocular musculature. Nuclear palsy of the 6th pair of cranial nerves is never isolated but associated with horizontal homolateral gaze palsy. The nuclear palsy of the IV pair of cranial nerves cannot be distinguished from a palsy owed to an injury of its trunk portion. The most frequent etiopathogenesis of fascicular palsy (the alternating syndrome) of the
oculomotor nerves is vascular, due to the occlusion of one or more branches going from the posterior cerebral artery to the midbrain, and from the vertebrobasilar artery to the pons, respectively. A list of systemic syndromes results, which are distinguished by the names of the authors who first described them.
• Weber’s syndrome: it is characterized by a complete paralysis of the third cranial nerve on one side and contralateral hemiplegia. It is secondary to a single-lateral mesencephalic lesion, in which the posterior part of the cerebral peduncle is damaged with the involvement of the pyramidal tract above its crossing.
• Benedikt syndrome: it consists in the one-side III cranial nerve palsy associated to hemianesthesia and contralateral tremors. It is secondary to a single-lateral injury of the midbrain interesting the fasciculus of the III pair of cranial nerves as well as the red nucleus.
• Claude’s syndrome: it is the paralysis of one-side III cranial nerve combined with ipsilateral tremor and contralateral hemiplegia. It depends on a homolateral lesion of the area comprising the fasciculus of the III pair of cranial nerves, the red nucleus and the cerebral peduncle. It is usually secondary to the occlusion of a branch of the posterior cerebral artery.
• Nothnagel syndrome: it features the paralysis of the III cranial nerve as well as contralateral cerebellar hemiataxia. It results from the damage of the third cranial nerve root, of the upper cerebellar peduncle and of the red nucleus.
• Millard-Gubler syndrome (or ventral pontine syndrome): it consists of the paralysis of the sixth and seventh cranial nerve on one side associated with a contralateral hemiparesis. It is secondary to the injury of the lower part of the pons on the same side with the involvement of the fascicular portions of the VI and VII cranial nerve and the pyramidal bundle.
• Foville syndrome (or dorsolateral pontine syndrome): it shows up with the same symptoms as Millard-Gubler syndrome, with which horizontal gaze palsy on the same side of the lesion due to the involvement of the horizontal gaze center is associated.
• Raymond-Cestan syndrome: it is the paralysis of the VI cranial nerve with contralateral hemiplegia due to damage of the nucleus and the pyramidal bundle of this nerve.
Root paralysis affects the tracts of the oculomotor nerves emerging from the brainstem. In case of involvement of the third cranial nerve, interpeduncular space syndrome occurs, characterized by complete bilateral paralysis of the nerve, sometimes with contralateral hemiplegia. Root paralysis of the IV cranial nerve can also be bilateral and those of the VI are often associated with facial paralysis on one side.
The trunk paralysis is owed to the fact that the trunk portions of the oculomotor nerves (going through the subarachnoid space, the extradural space, the cavernous sinus and the superior orbital fissure) can be simultaneously affected by pathogenic processes in the skull base. This explains why the trunk paralysis are associated each other and with other neurological symptoms, also giving rise to syndromes such as that of the cavernous sinus. The latter is characterized by complete ophthalmoplegia, caused by palsy of the III, IV and VI pair of cranial nerves; it is associated with pain and hypoesthesia in correspondence of the areas of distribution of the first two branches (ophthalmic and maxillary) of the trigeminal, if the lesion affects the posterior portion of the cavernous sinus -only the first branch is involved in case of affection of the anterior portion of the sinus.
The group of myogenic paralysis includes oculomotor muscles palsies resulting from primitive myogenic conditions.
Ocular Myasthenia gravis (or Erb-Goldflam disease) affects subjects between the ages of 15
and 20, but it can occur at any age, with prevalence of females in the juvenile form (2:1 compared to males). Forms that arise in adulthood are equally distributed in the two sexes. Eye motility disorders are present in at least 90% of cases if the disease has previously manifested with the involvement of other muscular areas, while in 50-60% of cases they represent the first symptom. The most frequent ocular symptom is monolateral or bilateral, often asymmetric, ptosis, secondary to the weakness of the levator palpebrae and of the frontalis muscle resulting in a difficulty for lifting the eyebrow. Ptosis is associated with a certain inability to close the eyes due to insufficient orbital muscles. When ptosis is not evident, the patient may be asked to open and close his eyes repeatedly for 15-20 times. In the case of myasthenia, fatigue of the levator palpebrae often causes ptosis.
Lambert-Eaton myasthenic syndrome consists of weakness and pain of limbs and is secondary to a neuromuscular transmission disorder. The onset is subacute and variable in its progression; trunk, pelvic belt and shoulder muscles are most frequently affected. Muscles innervated by cranial nerves are more rarely concerned, even if sometimes the disease begins with diplopia, ptosis, dysarthria and dysphagia, due to the involvement of these ones.
Myasthenic-like syndromes result from the use of antibiotics or other drugs. They are characterized by diplopia, visual clouding due to poor accommodation associated with ocular muscles failure following the use of curare-like drugs, phenothiazine, phenytoin, procainamide or some of the more recent ganglio blocking medications. In addition, myastheniform syndromes are sometimes secondary to the intake of antibiotics such as streptomycin, neomycin, polymyxin B, kanamycin, bacitracin or colistin.
Progressive external ophthalmoplegia (PEO) is a group of degenerative, hereditary and progressive muscular dystrophies responsible for strabismus fixus and classified according to the clinical symptoms and signs, the type of Mendelian inheritance, the presence of the abnormal gene as well as its locus, and the “product” of the altered gene. This group of diseases includes, in addition to PEO, Duchenne/Becker dystrophy, Emery-Dreifuss dystrophy, myotonic dystrophy, proximal myotonic myopathy, congenital muscular dystrophy, facioscapulohumeral muscular and scapuloperoneal muscular dystrophy, Erb type muscular dystrophies, distal myopathies and oculo-pharyngeal dystrophy. PEO is the only one of the above-listed muscular dystrophies to be caused by a macrodeletion of mitochondrial DNA (Figure 26). It may also be associated with retinitis pigmentosa and cardiac conduction disorders which can cause sudden death from cardiac arrest. Cardiac and ocular myopathies represent the main characteristics of this disease (Kearns-Sayre syndrome)21 .
Oculo-pharyngeal muscular dystrophy, particularly common in patients of French-Canadian

origin, is a form of autosomal dominant hereditary ophthalmoplegia, for which a genetic defect has been described in a locus of chromosome 14q11.2-14q13. It occurs around the age of 50-60 and the symptoms consist of bilateral ptosis with gradual onset and paralysis of extra-ocular motility.
Myotonic dystrophy (Steinert disease), an autosomal dominant family-borne disease, is secondary to a genetic defect located in a single locus of chromosome 19q13.3. The disease begins towards the third decade of life, rarely during childhood or before. Ocular motility disorders consist of bilateral ptosis almost always associated with weakness of the orbital muscles and myotonic closure of the eyelids; temporal, masseter, sternocleidomastoid and distal limb muscles are also affected.
Congenital myotonia (Thomsen’s disease): it has an autosomal inheritance due to a defect of the chloride channels gene located on chromosome 7. It is divided into myotonia congenita (Thomsen disease), with dominant inheritance, and generalized myotonia (Becker disease), with a recessive inheritance, respectively. The features of congenital myotonia is the tonic muscle spasms after voluntary contraction; both oculomotor and sometimes orbicularis muscles may be affected, so that a strabismus follows; after crying, the affected child has difficulty opening his eyes. In severe cases, this phenomenon is manifested after a simple sneeze. Patients with congenital myotonia are considered at risk of malignant hyperthermia following narcosis.
Strabismus fixus: several clinical entities characterized by ocular motility alterations secondary to fibrosis of the oculomotor muscles are actually classified in the Congenital Cranial Dysinnervation Diseases which include also the following.

Duane retraction syndrome which has been divided into three types, referred to as I, II, III.
Duane type I consists in the impossibility to abduct an eye. Adduction is normal but accompanied by narrowing of the palpebral rime and globe retraction. This type is the most common. Duane type II manifests itself with the complete absence of adduction of the affected eye, associated with narrowing of the palpebral fissure and globe retraction in the attempt to adduct. Abduction is normal.
Duane type III consists of the total absence of adduction, exophoria in primary position, appearance of narrowing of the palpebral rime and globe retraction in adduction attempts.
In the Duane’s syndrome, cranial nerve aplasia was found during the autoptic examination, while in the living patient aplasia or hypoplasia of the cranial nerve on the same side of the lesion has been detected by magnetic resonance imaging.
The superior oblique tendon sheath syndrome (Brown syndrome) consists in the inability to lift during the adduction of the eye.
Moebius syndrome (congenital bulbar palsy) is a congenital, rarely familiar, syndrome, characterized by facial diplegia (VII cranial nerve) and horizontal gaze paralysis (VI cranial nerve), often with esotropia (Figure 27)22
Congenital Fibrosis of the Extaocular Muscles (CFEOM) is a congenital condition where aptients are unable to move their eyes in all the directions. It is transmitted as a recessive or X-linked trait and therapy is usually symptomatic.
Appropriate therapy for paretic strabismus will be discussed and detailed elsewhere. We only remind young ophthalmologists to keep in mind that surgery for paretic strabismus must be performed after that the angle of strabismus has been documented as stable without variations since at least 6-9 months (i.e during the concomitant phase).So, be patients with your patient: this is a crucial point!
References
1. Simon J. Hickman, Axel Petzold: Update on Optic Neuritis: An International View. Neuro-ophthalmology 2022, 46; 1: 1–18
2. Wingerchuk DM, Banwell B, Bennett JL, International Panel for NMO Diagnosis. International consensus diagnostic criteria for neuromyelitis optica spectrum disorders. Neurology 2015;85:177–89.
3. Brenda Banwell*, Jeffrey L Bennett*, Romain Marignier, et al. Diagnosis of myelin oligodendrocyte glycoprotein antibody-associated disease: International MOGAD Panel proposed criteria. Lancet Neurol 2023; 22: 268–82
4. Arturo Carta, Paolo Mora, Antonio Pinna, Alfredo A Sadun. State of the art on traumatic optic neuropathy. Exp Rev Ophthalmol 2008; 3(1): 77-84.
5. Hayreh SS. Ischemic optic neuropathies - where are we now? Graefe’s Arch Clin Exp Ophthalmol. 2013 Aug;251(8):1873-84.
6. Matilde Roda, Natalie di Geronimo, Marco Pellegrini, Costantino Schiavi. Nutritional Optic Neuropathies: State of the Art and Emerging Evidences. Nutrients. 2020 Aug 31;12(9):2653. doi: 10.3390/nu12092653.
7. Carelli V, La Morgia C, Yu-Wai-Man P. Mitochondrial optic neuropathies. Handb Clin Neurol. 2023;194:23-42. doi: 10.1016/B9780-12-821751-1.00010-5
8. Carelli V, Ross-Cisneros FN, Sadun AA.Mitochondrial dysfunction as a cause of optic neuropathies. Prog Retin Eye Res. 2004 Jan;23(1):53-89.
9. Jonathan A. Micieli, Nancy J Newman, Valerie Biousse. The role of OCT in the evolution of compressive optic neuropathies. Curr Opin Neurol 2019 Feb: 32 (1): 115-123.
10. Victoria Lee, Asim V Farooq, Hassen A Shan. Leukemic and Lymphomatous optic neuropathy: a case series and review of the literature. J Neuroophthalmol 2021 Dec. 1(4): e796-e802.
11. Arturo Carta, Paolo Mora, Raffaella Aldigeri, et al. Optical coherence tomography is a useful tool in the differentiation between true edema and pseudoedema of the optic disc. PLoS ONE 2018; 13(11): 1-9. doi.org/10.1371/journal.pone.0208145
12. Dana Al-Baden, Alya Hasan, Raed Behbehani. Sellar masses: diagnosis and management. Frontiers in Ophthalmology 2022 Nov: 24(2): 970580.
13. Walton KA, Buono LM. Horner syndrome. Curr Opin Ophthalmol. 2003 Dec;14(6):357-63.
14. A Kawasaki Physiology, assessment, and disorders of the pupil. Curr Opin Ophthalmol 1999 Dec;10(6):394-400. doi: 10.1097/00055735-199912000-00005.
15. Oddo M, Taccone FS, Petrosino M, and the ORANGE study investigators.The Neurological Pupil index for outcome prognostication in people with acute brain injury (ORANGE): a prospective, observational, multicentre cohort study. Lancet Neurol. 2023 Oct;22(10):925-933.
16. Strupp M, Kremmyda O, Adamczyk C, Böttcher N, Muth C, Yip CW, Bremova T Central ocular motor disorders, including gaze palsy and nystagmus.J Neurol. 2014 Sep;261 Suppl 2(Suppl 2):S542-58.
17. Yamaki VN, Solla DJF, Ribeiro RR, da Silva SA, Teixeira MJ, Figueiredo EG.Papillary Tumor of the Pineal Region: Systematic Review and Analysis of Prognostic Factors. Neurosurgery. 2019 Sep 1;85(3):E420-E429. doi: 10.1093/neuros/nyz062
18. Virgo JD, Plant GT Internuclear ophthalmoplegia. Pract Neurol. 2017 Apr;17(2):149-153.
19. “Il Nistagmo”, chapter XV in “Neuroftalmologia” by Francesco Carta and Arturo Carta, Monduzzi Eeditoriale 2015; pages 535551.
20. “Le paralisi miogene”: chapter XVII in “Neuroftalmologia” by Francesco Carta and Arturo Carta, Monduzzi Eeditoriale 2015; pages 643-660.
21. Orsucci D, Angelini C, Bertini E, Carelli V, et al. Revisiting mitochondrial ocular myopathies: a study from the Italian Network. J Neurol. 2017 Aug;264(8):1777-1784. doi: 10.1007/s00415-017-8567-z.
22. Arturo Carta, Paolo Mora, Alberto Neri, et al. Ophthalmologic and Systemic Features in Möbius Syndrome. Ophthalmology 2011; 118:1518–15
Paolo Nucci, Andrea Lembo, Celeste Limoli
As we know, a refractive defect is something that differs from emmetropia, a condition where a beam of light parallel to the optical axis is focused on the retina in the absence of accommodation. The majority of babies born hyperopic, but that doesn’t mean that they need to wear glasses. Children who show early symptoms of alteration of the ocular district (for example, evidence of strabismus or abnormalities in ocular motility) or with a marked familiarity are considered at risk of a refractive defect to correct. What are the most common refractive defects in children? When do these defects need to be corrected? When the risk of amblyopia is high and a strabismus is present, we should think about an optical correction: in the treatment of amblyopia it is necessary to consider the correction of the whole associated refractive error before the patch.
The term “amblyopia” refers to an unilateral or, less commonly, bilateral reduction in best corrected visual acuity, not directly attributed to a structural abnormality of the eye or posterior visual pathways during the first years of life [1]. Amblyopia is clinically defined as a reduced visual acuity accompanied by one or more known amblyogenic factors, such as strabismus, anisometropia, bilateral high refractive error, and a stimulus of deprivation like cataract. Early diagnosis of amblyopia is fundamental to obtain a good response to treatment. Most ophthalmologists recognize the visual maturity approximately at 8-9 years old, after this age the treatment could be ineffective. Amblyogenic factors interfere with normal development of the visual pathways during a critical period of maturation. The result is a structural and functional impairment of the visual cortex, and a impaired form vision [2]. Even though it can be bilateral, amblyopia most commonly affects one eye of children with strabismus, anisometropia, or both. Many studies have tried to delineate the prevalence of amblyopia in the world population: today we know that this value is between 2% and 5% of people. Many risk factors have been investigated over the years as a cause of amblyopia; among the most frequent findings, we can mention: prematurity, small for gestational age, first degree relative with amblyopia, developmental delay, drug or alcohol use during pregnancy. Strabismus or anisometropia account for about 40% of amblyopia each, with just over 20% of amblyopia in children with both strabismus and anisometropia [3]. Strabismus is the overwhelmingly factor most associated with amblyopia during the first year. Anisometropia, either alone or in combination with strabismus, becomes equally prominent as a cause of amblyopia after the third year. Amblyopia can then be caused by an opacity such as a congenital cataract or any other congenital ocular malformation. Current treatments for amblyopia rely on depriving the healthy fellow eye of vision to force the use of the amblyopic eye. The assumption is that the primary deficit in amblyopia is a monocular visual acuity deficit caused by preference for fixation by the fellow eye. By depriving the fellow eye, suppression of the amblyopic eye is eliminated and visual experience will promote development or recovery of
visual acuity. Patching, atropine, and filters that penalize the fellow eye have been used to treat amblyopia for hundreds of years [4]
Only in the last 15 years some randomized clinical trials have been conducted to evaluate the effectiveness of amblyopia treatment and to define optimal treatment protocols. The Pediatric Eye Disease Investigator Group (PEDIG) conducted a series of randomized clinical trials of amblyopic treatment for children ages 3–17 years old [5] .
The necessity for a formal eye examination for all children before the start of kindergarten remains a topic of debate, with most pediatric ophthalmologists adopting the position that screening may be successfully accomplished by primary care physicians and through school screenings.
Another relevant topic in pediatric ophthalmology is about refractive errors, and in particular myopia, extensively studied in the last few years.
Myopia is one of the most common refractive defects, constantly increasing. Currently, it is estimated that about one in four Italians is myopic, and some countries in the world have now

reached peaks of 85% of myopic people. The WHO has emphasized this phenomenon for several years, since high myopia is a major cost for health budgets. There is not only a socio-economic burden, but there are also significant increased odds ratios for myopic maculopathy, retinal detachment, cataracts, and glaucoma, even for low and moderate levels of myopia. The worldwide increase in myopia seems to be correlated with the increase in work activities closely [7] .
The increased prevalence of myopia is significant mainly in the school population: prolonged near-work during the study plays, in addition to hereditary factors, a fundamental role in the progression of myopia. With “juvenile myopia” we define an incorrect balance between the dioptric power of the cornea / lens and axial length that occurs during the age of ocular development. The forms of school myopia represent about 60% of the total amount, and often progress to exceed – 6,00 diopters, the limit for defining high myopia. For this reason, identifying an effective therapy to contrast myopia has been an indispensable issue.
The principle of treatment starts from the assumption that near work inhibits the release of dopamine, a neurotransmitter produced in the retina under the effect of natural light, which plays a strategic role in the transmission of images to the brain and can prevent excessive eye’s growth. There are many evidences for the role of the peripheral retina in the development of refractive errors and some studies suggested an association between relative peripheral hyperopia and axial myopia in Caucasian population. In contrast, the Peripheral Refraction in Preschool Children (PREP) Study of Singaporean Chinese children and Collaborative Longitudinal Evaluation of Ethnicity and Refractive Error (CLEERE) study showed that relative peripheral hyperopia had little consistent influence on the risk of myopia onset, myopia progression, or axial elongation. Even human clinical trials with treatment strategies aimed at reducing the peripheral retinal hyperopic defocus, there were no statistically significant differences in the rates of myopia progression between children who wore one of three focus spectacle lenses that decreased relative peripheral hyperopia and those who wore the conventional single-vision spectacle lenses. However, for children aged 6–12 years whose parents are myopic, one of the three spectacle lenses was found to reduce the progression of myopia significantly when higher rates of progression were evident.
The first useful treatment for myopia is to prescribe an adequate optical correction, first correcting the entire defect, but not following a glasses modification at each medical examination.
As for pharmacological treatment, the effect of Prinzepin on animal models have been studied in the past, then not continued on humans due to so many adverse effects. The breakthrough occurred with the ATOM studies (Atropine for the Treatment of Childhood Myopia, from 2006 onwards) and the ocular administration of a dilution of atropine, a non-selective acetylcholine antagonist [8]. Elevated properties as a cycloplegic were already known, while not considering the improvement of prolonged near-work. Atropine blocks non selectively muscarinic receptors in human cliary muscle, retina and sclera. Although the exact mechanism of atropine in myopia control is not known yet, it seems to act directly or indirectly on the retina or sclera by inhibiting thinning or stretching of the scleral, and thereby the eye growth. However, atropine 1% eye drops created too many side effects in the child, first of all intense photophobia and the need to move objects too far away to be able to focus on them. Moreover, when atropine was stopped, there was an inverse increase in myopia, with a grate rebound. Subsequent study protocols (ATOM2) showed that the same advantage could be obtained with a concentration of 0.01% of atropine while avoiding the adverse effects of the patient. This treatment demonstrated a reduction in myopic progression in the treated eyes after only six months of treatment, with negligible side effects [9]. Nowadays, we can assert
that ATOM is a pharmacological gold standard for all school-age children who showed a high index of myopia during ophthalmological examinations from the early years of development.
Nystagmus and Strabismus
Pediatric ophthalmology does not only deal with refractive errors in the age of development, it is also a branch of ophthalmology in its own right, where ocular pathologies are often different in diagnosis and treatment compared to adults’ pathologies. A clinical situation often considered complicated due to the difficulty of a correct diagnosis classification is infatile nystagmus.
Infantile nystagmus syndrome (INS), previously named as “congenital nystagmus”, is an oculomotor disorder of unknown etiology depending on instability of the smooth pursuit control system and characterized by rhythmic involuntary to-and-fro oscillations of the eye. It usually presents at birth or early infancy, and rarely develops later in life [10]. Incidence varies enormously, although the generally quoted is 1 in 6550 [11]. It can be inherited or sporadic, frequently associated with other congenital or acquired defects in the visual sensory system determining fixation’s deficits such as albinism, aniridia, achromatopsia, retinal dystrophies, optic nerve hypoplasia, or congenital cataract [12] .
INS is often characterized by involuntary oscillations on the horizontal plane, with potential vertical components: although INS usually exhibits a horizontal oscillation, a torsional component is also observed in most patients. In every patient affected by INS, it is possible to define a point in the space characterized with the lowest level of oscillation and the best vision possible (null point). Usually, the null point corresponds to the eyes’ configuration in primary position, so that patients don’t show an anomalous head posture (AHP) [13]
Another clinical aspect is the “neutral point”, defined as the eyes’ position in which a reversal of direction of jerk nystagmus occurs and in which no nystagmus, any of several bidirectional waveforms, or pendular nystagmus is present. Nystagmus intensity increases with fixation, decreases with convergence (convergence damping) and disattention, and disappears during sleep [14]. Children with INS do not suffer from oscillopsia, an illusory oscillatory movement of the environment, but they often have diminished visual acuity, inversely related to the intensity of the nystagmus; furthermore, in patients with other sensory deficits, the nystagmus contributes to further loss in acuity [15]
Normal saccadic movements and gaze control demonstrate that INS depends on smooth pursuit. The aim of saccadic movements is always corrective, as they represent a central nervous system trying to reduce the nystagmus. Such rapid movements allow patients thorough “refoveation” [16]
INS is not the only onset of nystagmus in the child; a correct approach to properly identify INS is based on the Classification of the Eye Movement Abnormalities [17], but a certain diagnosis is only based on video-oculography (VOG); clinical observations can hardly be determined in differential diagnosis, considering the different types of existing nystagmus. The most common types of infantile nystagmus are INS, fusion maldevelopment nystagmus syndrome (FMNS), spasmus nutans syndrome (SNS), asymmetric (a) periodic alternating nystagmus, characterized by cyclical null point shift causing recurrent modifications in oscillation width and direction.
SNS is typically characterized by short width, high frequency (>10 Hz), unconjugated, pendular, monocular and asymmetric waves. It is often associated with head nodding and torticollis, and it usually disappears within the first 30 months of life. If SNS develops in children over 3 years of age, it could suggest the presence of a solid cerebral neoplasia, which has to be investigated through MRI. Differential diagnosis between INS and FMN is based on the pres-

Figure 1. A schematic illustration of nystagmus waveforms (A) pendular nystagmus, (B) an accelerating velocity exponential slow phase jerk nystagmus (INS), (C) a decelerating exponential slowphase jerk nystagmus (FMN), (D) a linear or constant velocity slow phase jerk nystagmus (FMN). In (A) a slow phase is followed by a slow phase while in (B)–(D) a slow phase is followed by a fast phase [14]
ence of a latent component-nystagmus beating in the direction of the fixing eye- in half of the cases of INS, while it is always present in FMN. Similarly, a form of strabismus is present in half of patients affected by INS, while it is always present in FMN. AHP in patients with INS is more frequent than FMN, in which it depends on adduction-null or hunter position: the oscillations intensity is the lowest in adduction, with improvement of vision, while it is the opposite during abduction.
In order to distinguish through these conditions in patients affected by nystagmus, AHP and strabismus at the same time, the application of Hertle’s algorithm could be useful [18]:
1) the first step is to reposition the patient’s head to the neutral position and observe the consequences on the strabismus or the nystagmus;
2) the second step is to observe whether the change improves or worsens the condition (the major clinical differentiation occurs at this step);
3) if the nystagmus is worse, then differentiating between a gaze null due to INS and an adduction null due to FMN can be made by looking at the fixing eye’s effect
4) or the opposite non-fixing eye’s effect on the oscillation in abduction and adduction.
The therapeutic approach to patients with congenital nystagmus is based on medical treat-
ment, use of spectacles or contact lenses, and surgery. Patients’ expectations on nystagmus’ improvement are often represented by reduction of oscillations, which only relates to an aesthetic point of view. Visual acuity improvement should not be considered the only outcome in nystagmus’ management, as visual perception globally depends on other factors: images’ stability in the visual field, time needed to foveate, duration of the period of distinct vision along nystagmus’ cycle, areas of highest foveation quality. Furthermore, it is not unexpected to find out that after surgery for nystagmus patients report visual improvement, even without a corresponding increase in reading optotypes lines, as an additional confirmation of the importance of the psychological condition of the patient.
The first surgical procedure for nystagmus has been developed by Anderson, and then modified and improved by Kestenbaum, consisting of a double recession/resection of horizontal rectus muscles [19]. Null point is shifted from eccentric position to primary position, so that AHP can be minimized. Surgery is usually indicated in patients with INS and AHP due to an eccentric null gaze position, those with strabismus, or those which have good binocular function and whose nystagmus decreases and vision improves during convergence (convergence damping).
Later, Dell’Osso and Herte described a new surgical approach [20]: all extraocular muscles were surgically tenotomized and immediately reattached to their original insertions in some different stages (T&R surgery). After each stage of this new procedure, patients showed persistent visible, behavioral, and oculographic changes. These included damped INS and see-saw nystagmus SSN, increased ability to maintain fixation, and increased periods of target image fixation on the area centralis over a broad range of gaze angles. Today it is known that reattaching the tendons of the extraocular muscles affect some as-yet-unknown combination of central nervous system processes producing the above results. This new procedure may prove effective in patients with INS with either no null, a null at primary position, or a time-varying null (due to asymmetric, (a) periodic, alternating nystagmus). In other words, T&R surgery determines anatomical detachment of proprioceptive nerve endings involved in the control of extraocular muscles rest tension, as they are particularly abundant laterally in the muscles. The procedure has no consequences on saccades, and it seems to be useful even in acquired pendular nystagmus.
Pediatric strabismus includes multiple clinical presentations, here we describe the most common onsets.
Essential infantile esotropia (EIE) is an ocular motility disorder defined as the fixed crossing of the eyes in otherwise neurologically normal children within the first 6 months of age. It results in a binocular misalignment in which one (or both) eye is deviated nasally. The condition is occasionally present at birth, hence the additional name of congenital esotropia. The incidence of infantile esotropia is reported to be approximately 1%, therefore it is worthy of consideration in the strabismus field [21]
EIE is a sporadic disease of multifactorial etiology, prevailing among children with a positive family history of strabismus. Significant risk factors associated with the disorder are prematurity, pre- and perinatal complications as well as systemic diseases. The cause is still a matter of active research and can be traced back to any part of the visual system, from the extraocular muscles to the visual cortex. EIE generally develops during the first months of life. In children aged less than 3 months pseudoesotropia, i.e. transient ocular misalignment, is common and therefore should be considered. A comprehensive ophthalmologic evaluation with examination of motility and alignment is required for the appropriate diagnosis. EIE is characterized by a constant angle of deviation usually greater than 30 prism diopters (PD) and accompanied by other clinical findings that appear most frequently after 2 years of age [22]:



– A mild hypermetropia less than +3.00 D with mild astigmatism is usually present. The refractive error is relatively stable in the first decade of life;
– An apparent limitation of abduction due to cross fixation can be observed upon initial examination of eye movements;
– Dissociated vertical deviation (DVD) affects approximately 75% of cases and consists of an elevation of the non-fixing eye when covered. It can also be developed a dissociated horizontal deviation (DOD) and dissociated torsional deviation (DTV), but less frequently;
– Inferior oblique overaction is common, occuring in approximately 70% of the affected children, and consists of an over-elevation of the eye in supra-adduction;
– FMN affects roughly 40% of cases;
– Amblyopia may develop in up to 50% of cases.
Other disorders that can be displayed with esotropia should be considered in the differential diagnosis with infantile esotropia. The most common are the following:
– Accomodative esotropia (AE) is an intermittent ocular motility disorder that appears approximately after the first six months of age and is usually accompanied by a significant hyperopia, greater than + 3.00 D. Spectacles are the treatment of choice for the full cycloplegic refraction;
– Sensory esotropia develops in older children with unilateral sensory visual deprivation because of different organic disorders;
– Restrictive esotropia determines incomitance and AHP;
– Congenital six nerve palsy causes an abduction deficit and esotropia of the injured eye;
– Duane syndrome is associated with limited abduction, a small-angle esotropia in primary gaze and an abnormal face turn. The affected eye has a palpebral fissure narrowing on adduction;
– Congenital fibrosis of the extraocular muscles frequently induces poor ductions and ptosis;
– Medial wall fracture as a cause of esotropia can be easily differentiated by collecting the history of trauma: it causes AHP and incomitance;
– Nystagmus blockage syndrome is characterized by esotropia and moderate nystagmus when the patient is attentive, while by manifesting nystagmus when inattentive. Miosis observed during esotropia can help in making this diagnosis.
Currently, the treatment for most cases of EIE is the realignment of extraocular muscles by traditional incisional surgery. As an alternative to surgery, botulinum toxin injected into the medial rectus has been suggested for the treatment of infantile esotropia: the efficacy is better in children with small angles of deviation and the effect is often transitory. In order to correct the hyperopia greater than +2.50 D or the anisometropia greater than 1.50 D, corrective lenses can be prescribed to eliminate the superimposed refractive esotropia. Ambyopia may be addressed with conventional occlusion therapy, to improve the vision in the weaker eye. The most common surgical approach for EIE is bilateral medial rectus recession (MRrec) to
enable the ocular realignment by weakening the adduction action of medial recti. As an alternative, a MRrec combined with a lateral rectus resection (LRres) of the same eye can be performed, yielding similar results. Clinical conditions associated with EIE, including inferior oblique overaction and DVD should be addressed surgically when they appear. The best timing of strabismus surgery is still debated, however it is recommended to perform early surgery in order to preserve the proper sensory and ocular motor development during the first critical months of life [23]. Multiple studies have shown that children operated early have a better potential for binocular vision and good stereopsis, compared to those operated later. However, an earlier correction is technically more difficult as surgical procedure, due to the smaller size of the orbit, the unstable deviation and imprecise measure of the alignment. For these reasons, multiple surgeries may be required to achieve orthotropia. A close follow-up should be programmed to assess eye realignment, monitor the healing process and rule out amblyopia. The most commonly noted complications are under- and over-correction, even though they are frequently transient.
Accommodative esotropia (AE) is a form of strabismus characterized by convergent misalignment of the visual axes that is typically associated with hyperopia and/or abnormal fusional divergence. It typically presents between ages 1.5 and 4 years as an intermittent esodeviation, exacerbated by fatigue or near viewing [24]. AE is the most common form of childhood esotropia. The prevalence of AE has been estimated to be approximately 1-2% in the United States [25]. Although treatment with optical correction (hyperopic correction and/or bifocals) is usually successful in restoring ocular alignment, strabismus surgery is required in approximately one third of cases.
AE can be classified into three types:
– Pure refractive AE
– Partially accommodative or decompensated esotropia (PAE), if residual esotropia remains in spite of full hyperopic correction
– AE with an increased accommodative convergence to accommodation ratio (AC/A ratio). In children with an uncorrected high hyperopia, the accommodative effort allows to bring the image back to focus on the retina; however, accomodation stimulates an increased convergence and ET in presence of insufficient fusional divergence. AE is an acquired condition

with a hereditary basis, but no specific pattern of inheritance has been detected. AE initially shows an intermittent onset, then becomes constant over time. It is important to investigate the occurrence of either trauma or illness, because they can act as trigger events.
Parents report that the infant’s eyes are straight, but when their children accommodates to focus at near or is tired, one or both eyes cross inward, developing esotropia. Older children can rarely experience asthenopic symptoms, including headaches or diplopia; the latter symptom disappears right after it has developed a suppression scotoma. The deviation angle is variable, typically between +20 and +40 PD. When this disorder becomes constant, binocular vision loss and amblyopia usually occur. An accurate cycloplegic refraction is necessary to diagnose the correct refractive error. It is usually a moderate hyperopia between + 2.00 and +6.00 D. In infants with high AC/A ratio refractive errors range from high hyperopia to myopia. AE should be distinguished from EIE, which occurs earlier and has greater angle of deviation. In addition, it must also be distinguished from other symptoms: intermittent esotropia, acquired non-accommodative esotropia, cranial Nerve VI palsy and Duane Syndrome. The main treatment consists in full hyperopic correction with spectacles, based on the cycloplegic refraction. It should be prescribed as soon as the strabismus occurs, in order to prevent loss of stereopsis and amblyopia. Medical follow-up is required as monitoring. If the patient regains good fusion with the full correction, the diagnosis of pure refractive AE can be confirmed. The hyperopic error gradually reduces as the child grows and the weaning process from the refractive correction can be initiated. If residual esotropia remains despite correction with spectacles, patients show PAE and when the constant esodeviation is greater than +10 PD surgery is recommended. The most common surgical option consists of a bilateral MRrec [26]
In pediatric ophthalmology there are some clinical manifestations that we must never forget, and those differential diagnoses are important not only for a correct visual prognosis but also quoad vitam. Here following we list some cases to always remember in the correct management of an ocular problem in pediatric age.
Leukocoria refers to an altered white or pale pupillary reflex from the retina observed in one or both eyes, in contrast to the normal red reflex. The condition is generally caught within the first 4 years of life by a family members or incidentally on pediatric visits from birth, espe-


cially the newborn baby check that should include the examination of the pupils. It is often a sign of different serious intraocular disorders, among them distinguishes retinoblastoma, that may be life-threatening. Therefore, leukocoria should be promptly referred to a pediatric ophthalmologist to obtain a correct functional picture of the situation [27]. The normal pupillary reflex appears red due to the physiological reflection of choroidal vasculature through the dioptric media. Any disorder that interferes with these media would result in an abnormal red reflex, i.e. leukocoria.
A lot of ocular conditions may present with leukocoria; the differential diagnosis is wide, including neoplastic, developmental, infective, degenerative and traumatic disorders. Some of the most common are:
– Retinoblastoma, that accounts for the most frequent intraocular malignancy found in pediatric population. Presentation is generally with unilateral loss of red reflex of the eye, strabismus in about 20% of cases and rarely decreased vision in children aged 12-24 months of age. As much as 50% of cases show autosomal dominant transmission. Inherited forms are due to a germline mutation of the retinoblastoma protein tumor suppressor gene, tend to occur bilaterally and can affect children at much younger age [28]. Different growth patterns can be recognized, including: endophytic (with vitreous seeding), exophytic (associated with non-rhegmatogenous retinal detachment) or combined;
– Congenital cataract, that accounts for about 75% of the cases of leukocoria. It can be either unilateral and sporadic or, more often, bilateral and associated with systemic diseases, chromosomal anomalies, metabolic disorders and intrauterine infections;
– Coats disease, also known as exudative retinitis, that is a rare congenital, non-hereditary disorder characterized by retinal teleangiectasia. It commonly affects one eye in male patients, with a median age of onset at 8 years old. It may results in exudative retinal detachment, neovascular glaucoma, the most devastating complication, and bulb-like microaneurysms;
– Persistent hyperplastic primary vitreous (PHPV), referred to a rare congenital malformation of the eye. It is caused by a non-regression of the hyaloid vascular system, that should physiologically disappear at the time of birth. PHPV has an unilateral involvement, can present with microphthalmia and can lead to tractional retinal detachment, cataract or retrolental fibroplasia;
– Retinopathy of prematurity (ROP), also known as retrolental fibroplasia, that is a pathological proliferation of retinal vessels in premature babies under 30 weeks of gestational age or weighing less than 1500 grams. It is one of the most frequent causes of vision impairment in infants, potentially leading to lifelong blindness. ROP is usually bilateral and exposes the patient to certain complications later in life, including retinal detachment, myopia, strabismus, amblyopia and glaucoma. There is often a history of prolonged ventilatory support, considered one of the most important risk factor;
– Ocular infections, that cause leukocoria by the accumulation of inflammatory debris especially in the vitreous. Particularly noteworthy are pediatric uveitis and toxocariasis. Pediatric uveitis is mostly bilateral and associated with autoimmune and rheumatic diseases, such as juvenile idiopathic arthritis. Toxocariasis, usually unilateral, is caused by a nematode Toxocara canis hosted by dogs and cats; close contact of children with domestic pets is an important clue for diagnosing that infection;
– Coloboma, that results from an incomplete closure of the embryonic fissure. Most commonly, it occurs in the anterior segment involving the iris; it can also affect optic nerve, choroid and retina. The most important complication is retinal detachment;
– Familial exudative vitreoretinopathy, that is an autosomal dominant hereditary retinal vas-






cular disorder, characterized by peripheral areas of avascular retina, retinal ischemia with neovascularization, exudate formation and retinal detachments due to vitreous tractions. These hallmark features overlap with retinopathy of prematurity, but patients with familial exudative vitreoretinopathy have different characteristics – lack of preterm birth or low birth weight – and a family history of the diseases. There are some conditions that can mimic leukocoria, even if they are not featured by an altered pupillary reflex, such as pediatric glaucoma, strabismus, hypopyon, corneal opacities and hyphema.
A detailed clinical and family history, a complete ophthalmic examination, imaging, such as optical coherence tomography of the retina and B scan ultrasonography are mandatory in evaluating pediatric patients with leukocoria as most conditions are vision-threatening.
Congenital blepharoptosis or ptosis is the abnormal drooping of the upper eyelid falling to a lower position than normal. If the reduction of the vertical palpebral fissure is severe, it may interfere with vision, as it covers part or all the pupil, and cause amblyopia. Ptosis can be present since birth or later within the first year of life. The disorder, either unilateral or bilateral, is generally isolated, however it may be part of systemic conditions. Therefore, a thorough ophthalmological and physical evaluation is necessary to rule out serious medical problems, especially if the ptosis develops over a short time period. The upper eyelid’s elevation is mediated by the contraction of two muscles: the levator palpebrae superioris, that receives innervation from the superior branch of the III cranial nerve, and the superior tarsal muscle, that adjoins the other muscle and is innervated by sympathetic nervous system. Congenital ptosis may result either from a dysfunction/dysgenesis of the muscles or from developmental anomalies of the nerves that work to keep the upper eyelid raised. Histologically, the muscle fibers are likely to be infiltrated by fibrous and adipose tissues [29]. In most cases of isolated congenital ptosis, the cause is unknown. However, given the common familial pattern, chromosomal causes are likely. Both dominant and recessive forms have been reported. Congenital ptosis can be associated with other manifestations in systemic syndromes. In particular, congenital cranial dysinnervation disorders result from an abnormal innervation of ocular and extraocular muscles and comprise most commonly:
– Duane syndrome
– Blepharophimosis ptosis epicanthus inversus syndrome (BPES), an inherited dysmorphic syndrome that involve blepharophimosis, ptosis, epicanthus inversus, and telecanthus;
– Congenital fibrosis of the extraocular muscles, a group of genetic eye movement disorders characterized by opthalmoplegia affecting the vertical movements, ptosis and incomitant strabismus;
– The Marcus Gunn phenomenon, described as an unilateral blepharoptosis associated with upper eyelid movements that are synkinetic with jaw movements during mastication. Other common causes of congenital ptosis include:
– Congenital Horner’s syndrome, characterized by the unilateral involvement of the eyes with a potential combination of the following signs: pupillary myosis, ptosis, heterochromia iridum, enophthalmos, anhidrosis on the affected side of the face, contralateral hemifacial flushing, and headaches. The major cause of congenital Horner’s syndrome is dystocic delivery, often associated with brachial plexus injuries;
– Congenital myasthenic syndromes, a group of genetic disorders affecting neuromuscular transmission and all include ocular, bulbar and limb muscle weakness. In severe cases, neonate may suddenly develop respiratory failure for a decreased pulmonary function with episodes of apnea and cyanosis;
– Lymphedema-distichiasis-syndrome, a rare autosomal dominant disorder characterized by eyelids distichiasis, lymphedema of the extremities and congenital ptosis in 30% of cases;
– Kearns-Sayre syndrome, a rare multisystem mitochondrial deletion disorder that is most likely to begin before 20 years of age, but is rarely present at birth. Major features include progressive external ophthalmoplegia, ptosis, retinal pigmentation, and cardiac conduction defects;
– Periorbital tumor;
– Orbital pseudotumor, presenting with ptosis due to the inflammation and edema of the eyelid.
Besides the congenital variety, ptosis can be a manifestation of different acquired conditions that have usually a serious course [30]. They can be classified as follows:
– Neurogenic: third nerve palsy, acquired Horner’s syndrome;


– Myogenic: myasthenia gravis, chronic progressive external ophthalmoplegia, oculopharyngeal muscular dystrophy, myotonic dystrophy;
– Mechanical: eyelid tumours, multiple chalazions eyelid oedema, anterior orbital lesions. Finally, ptosis can have an acute onset, suggesting various disorders. The most typical are: – Bell’s palsy, an idiophatic isolated dysfunction of cranial nerve VII, presenting with unilateral sudden facial paralysis, ptosis, hyperacusis and a loss of taste sensation. Normal facial function is usually regained within 3 weeks;
–
Acute botulism, a foodborne disease caused by a neurotoxin produced by the bacterium Clostridium botulinum. Patients typically develop bilateral and symmetric weakness or paralysis that begins cranially and progresses in a descending pattern. Common neurological symptoms include ptosis, diplopia, blurred vision and diminished pupillary light reflex, dry mouth, dysphagia that can cause aspiration pneumonia, dysarthria. Respiratory failure is a potentially life-threatening complication. Early diagnosis and prompt therapy is crucial for survival;
– Recurrent ophthalmoplegic neuropathy. It is a rare condition characterized by attacks of unilateral headache followed by ophthalmoplegia that is typically reversible. The oculomotor nerve, followed by the abducens nerve, is commonly affected;
– Miller–Fisher syndrome. It is a variant of Guillain–Barré syndrome with an acute onset presenting as a triad of ataxia, areflexia, and external ophthalmoplegia. Anti-GQ1b antibodies are present in 80-90% of cases.
Congenital nasolacrimal duct obstruction (CNDO) is an occlusion of the nasolacrimal drainage system that occurs at birth. It is a relatively common pediatric disorder with an estimated prevalence ranging between 5 and 20% among the normal newborn infants [31]. It can be unilateral or bilateral up to a third of affected newborns. The nasolacrimal duct blockage is self-limitant as it resolves spontaneously in 90% of the cases. CNDO is caused by a membranous septum generally located at the valve of Hasner, distally to the end of the duct. Another common cause of blockage is the general stenosis of the duct. Premature infants are at increased risk of congenital nasolacrimal duct obstruction due to the inadequate development of the nasolacrimal drainage system during the intrauterine life. Other risk categories include infants with Down syndrome, craniosynostosis, clefting syndromes and other midline facial dysmorphologies. Although the obstruction is congenital, newborns begin to produce tears only after the first few weeks of life. As a result, the symptoms of blockage are not present at birth, delaying the diagnosis. The main symptom is the overflow of tears, known as epiphora. A history of tearing and regurgitation of purulent material into the eye is typical. Consequent-
ly, periocular dermatitis and recurrent conjunctivitis may develop. This clinical presentation should alert the pediatrician to the presence of congenital nasolacrimal duct obstruction. The diagnosis is confirmed by the fluorescein dye disappearance test, useful for assessing the presence of inadequate lacrimal outflow, especially if the disease is unilateral. CNDO is considered a benign disease, due to its spontaneous auto-resolution within the first year of life in most cases. For this reason, the first-line strategy is a conservative management, that consists of careful monitoring, lacrimal sac massage and topical antibiotics if bacterial infections occur. The lacrimal massage needs to be performed three or four times per day. If the duct obstruction persists, an invasive approach will be required. The most common surgical procedure is the probing of the nasolacrimal system. In this treatment, a probe with a varying diameter of between 0.7 to 1.1 mm is passed down to the distal tract of the system to restore the patency. Although the optimal timing of surgery is still debated, primary probing is commonly performed after the first year of life, if the conservative management fails. If the nasolacrimal obstruction persists despite the primary probing, repeating the surgical intervention is a viable second-line invasive strategy. However, it has a lower efficacy than primary probing. Major complications of this surgical treatment include nasal bleeding, duct restenosis and formation of a false passage of the duct. Nasolacrimal duct intubation is generally used after failed probing, with a high success rate. It is an invasive approach that consists of a silicone tube stent placement in one or both canaliculi. These stents are left in situ for a variable period time, ranging from 2 to 6 months. As an alternative to the above, balloon catheter dilation can be performed. Compared to nasolacrimal intubation, it has comparable success rates, but requires a more expensive equipment. Therefore, balloon catheter dilation is reserved for complex and persistent cases of obstruction. If all the above-mentioned treatment are ineffective, dacryocystorhinostomy surgical procedure represents the last resort for affected infants. It can be performed by either an external or endoscopic approach. The latter one is preferred, because has a higher success rate, decreased post-operative complications and course compared to the external approach.
A congenital cataract is any intraocular lens opacification which is usually identified at birth or in the first decade of life. It is one of the most prominent and reversible causes of childhood blindness, leading to the 10% of all vision impairment in children worldwide. It has been estimated that congenital cataract affects 1-6/10.000 livebirths in higher income countries and 5-15/10.000 ones in under-privileged countries [32]. The cataracts can involve one or both eyes in up to 2/3 of cases and their size, morphology, localization and degree of lens opacification can be widely variable. Therefore, the disease severity, treatment and prognosis can also be highly different. Establishing the cause of infantile cataracts is necessary to obtain a correct clinical picture of the situation. Therefore, a thorough workup that examines metabolic, infectious, systemic, and genetic history is required. The distinction between unilateral and bilateral cataracts is important when considering etiology. Most bilateral cataracts are inherited or associated with systemic disease. They can be the clinical feature of several genetic syndromes, such as Down syndrome, trisomy 13, trisomy 18, Turner syndrome. Systemic associations encompass metabolic disorders such as diabetes, hypocalcemia, Wilson disease and galactosemia, to name a few [33]. Other common causes that occur during pregnancy are intrauterine infections, including rubella, mumps and chickenpox, or drugs taken by the mother, such as corticosteroids and certain antibiotics (especially sulfa drugs).When the abovementioned causes are not identifiable, genetic mutations are likely responsible for pediatric cataracts. Over the last decade, with the recent advances in molecular genetics, causative mutations have been identified in genes different proteins, such as crystallins (i.e. intracellular lens proteins), connexins, aquaporins, transcription factors and cytoskele-
tal proteins. All patterns of inheritance have been observed, although autosomal dominant transmission is the most frequent [34]. In contrast, the majority of unilateral cataracts are of unknown etiology, although they may be the result of ocular dysgenesis, such as aniridia, anterior segment dysgenesis, persistent hyperplastic primary vitreous, micropthalmos, persistent fetal vasculature, posterior pole tumors, posterior lenticonus, retinopathy of prematurity. Finally, infants with suggestive signs of child abuse or trauma, known cause of pediatric cataracts, should be further investigated.
For a more in-depth discussion of the surgical management of pediatric cataracts, see the chapter dealing with surgery.
References
1. Raab EL. Amblyopia. In: Raab EL, editor. Basic and Clinical Science Course 2010–2011 Section 6: Pediatric Ophthalmology and Strabismus. San Francisco (CA): American Academy of Ophthalmology; 2010. p. 61–9.
2. Birch EE. Amblyopia and binocular vision. Prog Retin Eye Res. 2013; 33:67-84.
4. Loudon SE, Simonsz HJ. The history of the treatment of amblyopia. Strabismus. 2005; 13(2): 93-106.
5. Wallace DK. Evidence-based amblyopia treatment: results of PEDIG studies. Am Orthopt J. 2007; 57:48–55.
6. Patient Info. Vision screening recommendations. Available at: http://www.aapos.org/terms
7. Foster PJ, Jiang Y. Epidemiology of myopia. Eye 2014; 28(2): 202-8.
8. Chua WH, Balakrishnan V, Chan YH, et al. Atropine for the treatment of childhood myopia. Ophthalmology. 2006; 113(12):228591.
9. Chia A, Chua WH, Wen L, et al. Atropine for the treatment of childhood myopia: changes after stopping atropine 0.01%, 0.1% and 0.5%. Am J Ophthalmol. 2014; 157(2):451-457.
10. Wang ZI, Dell’Osso LF. Eye-movement-based assessment of visual function in patients with infantile nystagmus syndrome. Optom Vis Sci. 2009; 86(8):988-95.
11. Hertle RW, Dell’Osso LF, FitzGibbon EJ, Thompson D, Yang D, Mellow SD. Horizontal rectus tenotomy in patients with congenital nystagmus. Results in 10 adults. Ophthalmology 2003; 110(11):2097-105.
12. Khanna S, Dell’Osso LF. The diagnosis and treatment of infantile nystagmus syndrome (INS). Scientific World Journal. 2006; 6:1385-97.
13. Nucci P, Hertle RW. Anomalous head posturing in essential infantile esotropia: a hypothesis. Eur J Ophthalmol. 2012; 22(3):297-300.
14. Abadi RV, Bjerre A. Motor and sensory characteristics of infantile nystagmus. Br J Ophthalmol. 2002; 86(10):1152–60.
15. Leigh RJ, Dell’Osso LF, Yaniglos SS, Thurston SE. Oscillopsia, retinal image stabilization and congenital nystagmus. Invest Ophthalmol Vis Sci. 1988; 29(2):279–82.
16. Dell’Osso LF. Biologically relevant models of infantile nystagmus syndrome: the requirement for behavioral ocular motor system models. Semin Ophthalmol. 2006; 21(2):71-7.
17. Committee for the Classification of Eye Movement Abnormalities and Strabismus (CEMAS) Workshop. A Classification of Eye Movement Abnormalities and Strabismus (CEMAS): Report of a National Eye Institute Sponsored Workshop. in: 2001: 37–43; http://www.nei.nih.gov/NEWS/statements/cemas.pdf. (Accessed July 22, 2009)
18. Hertle RW, Zhu X. Oculographic and clinical characterization of thirty-seven children with anomalous head postures, nystagmus, and strabismus: the basis of a clinical algorithm. J AAPOS. 2000; 4(1):25-32.
19. Kestenbaum A. Nouvelle opération du nystagmus. Bull Soc Ophthalmol Fr. 1953; 6:599-602.
20. Dell’Osso LF, Hertle RW, Williams RW, Jacobs JB. A new surgery for congenital nystagmus: effects of tenotomy on an achiasmatic canine and the role of extraocular proprioception. J AAPOS. 1999; 3(3):166-82.
21. Wilson, EM., Saunders, R, Rupal, T. Pediatric Ophthalmology. Current Thought and A Practical Guide. 2009. Springer-Verlag Berlin Heidelberg
22. Nucci P. Lo strabismo: clinica e terapia. Manuale per oftalmologi ed ortottisti. Fabiano ed. 2003.
23. Simonsz HJ, Kolling GH, Unnebrink K. Final report of the early vs. late infantile strabismus surgery study (ELISSS), a controlled, prospective, multicenter study. Strabismus. 2005; 13(4):169-99.
24. Lembo A, Serafino M, Strologo MD, Saunders RA, Trivedi RH, Villani E, et al. Accommodative esotropia: the state of the art. Int Ophthalmol. 2019; 39(2):497-505.
25. Mohney BG. Common Forms of Childhood Esotropia. Ophthalmology 2001; 108:805–9.
26. Reddy AK, Freeman CH, Paysse EA, Coats DK. A data-driven approach to the management of accommodative esotropia. Am J Ophthalmol. 2009; 148(3):466-70.
27. Haider, S., Qureshi, W., & Ali, A. Leukocoria in children. Journal of pediatric ophthalmology and strabismus 2008; 45(3): 179180.
28. Shields, J. A., Shields, C. L. (2008). Retinoblastoma: Introduction, Genetics, Clinical Features, Classification. In Intraocular Tumors: An Atlas and Textbook (pp. 293-318). Lippincott Williams & Wilkins, Philadelphia, PA.
29. Pavone P, Cho SY, Praticò AD, Falsaperla R, Ruggieri M, Jin DK. Ptosis in childhood: A clinical sign of several disorders: Case series reports and literature review. Medicine (Baltimore). 2018; 97(36):e12124.
30. Berry-Brincat A, Willshaw H. Paediatric blepharoptosis: a 10-year review. Eye (Lond). 2009; 23(7):1554-9.
31. Vagge A, Ferro Desideri L, Nucci P, Serafino M, Giannaccare G, Lembo A, et al. Congenital Nasolacrimal Duct Obstruction (CNLDO): A Review. Diseases. 2018; 6(4):96.
32. Mohammadpour M, Shaabani A, Sahraian A, Momenaei B, Tayebi F, Bayat R, et al. Updates on managements of pediatric cataract. J Curr Ophthalmol. 201822; 31(2):118-126. [33].
33. Self JE, Taylor R, Solebo AL, Biswas S, Parulekar M, Dev Borman A, et al. Cataract management in children: a review of the literature and current practice across five large UK centres. Eye (Lond). 2020.
34. Berry V, Georgiou M, Fujinami K, Quinlan R, Moore A, Michaelides M. Inherited cataracts: molecular genetics, clinical features, disease mechanisms and novel therapeutic approaches. Br J Ophthalmol. 2020; 104(10):1331-1337.
Scientific literature is full of studies on ocular trauma; however, the vast majority of these are hindered by their retrospective nature and a non-homogeneous sample. Following the analysis on the various works on the subject, some consistent aspects emerge, particularly that [1,2-3]:
• Ocular trauma shows a bimodal age distribution, primarily affecting the late adolescent age group, 16-26 years, and the second group over 68 years old.
• Ocular trauma occurs in males with a frequency three to five times higher than in females.
• Ocular trauma is a significant cause of vision loss, especially in lower socioeconomic strata and underdeveloped countries.
• Ocular trauma is largely preventable with proper protective measures particularly in the workplace.
In the case of ocular trauma, the ophthalmologist is often the first physician to see the patient. Before focusing on the ocular examination, it is important to rule out the possible presence of life-threatening injuries. Once general medical stability is confirmed, it is good practice to ask patients about their general and previous ocular history to highlight any past ocular surgeries, gather information about ongoing medication therapy, allergies, and previous vaccination status against tetanus. It is crucial to gather information regarding the type of trauma, especially [4]:
1. Date, time, and place of the incident
2. Mechanism of the injury (metal on metal hammering, hit by a ball or punch, etc.)
3. Accidental, intentional, or self-inflicted injury
4. Context of the incident (work, sports, domestic environment, etc.)
5. Use of protection at the time of the incident
How the patient got injured is particularly useful for determining the level of suspicion for intraocular or intraorbital foreign bodies. It is essential to establish and classify ocular trauma with the correct terminology to avoid confusion among colleagues and to ensure the correct approach to it. Firstly, we should differentiate between closed globe trauma and open globe trauma.
Closed globe traumas represent the most significant category of ocular traumatic pathology, accounting for 3.7% to 13% of traumatic emergencies and 5% to 14% of hospital admissions in the pediatric field [5-6]. They can be caused by direct damage (site of impact) or indirect damage (intraocular structures). The mechanism by which a blunt object can cause ocular damage can be divided into four phases [7]:
1. Compression Phase (within 0.25 msec): This phase can lead to a reduction in the anteroposterior diameter of the eyeball by up to 60% of its original length.
2. Decompression Phase (between 0.25 and 1 msec): This phase is characterized by the maximum expansion of the equatorial diameter.
3. Rebound Phase (between 1 msec and 2.2 msec): There is an increase in the anteroposterior diameter by up to 112%, while the equatorial diameter decreases.
4. Oscillation Phase: Vibrations of the entire eyeball, including the cornea and intraocular fluids, occur at a frequency of approximately 85 cycles per second and subside within about 100 msec.
The Ocular Trauma Classification Group [8]differentiates the types of closed globe ocular trauma into:
• A. Contusion
• B. Lamellar Laceration
• C. Superficial Foreign Body
• D. Mixed And based on the zone of the injury:
• Zone I. External (limited to bulbar conjunctiva, sclera, cornea)
• Zone II. Anterior Segment (involving the structures of the anterior segment up to the posterior capsule of the lens, also includes the pars plicata but not the pars plana)
• Zone III. Posterior Segment (all internal structures posterior to the posterior capsule of the lens).
One of the most common ocular manifestations in cases of closed globe ocular trauma is hyphema. Hyphema, by definition, is the collection of blood or blood-related exudate in the anterior chamber. It is classified according to the amount:
• GRADE I: Blood occupies less than 1/3 of the anterior chamber.
• GRADE II: Blood occupies between 1/3 and half of the anterior chamber.
• GRADE III: Blood occupies half or more of the anterior chamber.
• GRADE IV: Blood completely fills the anterior chamber.
After excluding posterior injury with appropriate diagnostic tools, the treatment for post-traumatic hyphema includes placing the patient in complete rest, preferably in a sitting position or with the head raised at least 30°. Medications containing aspirin or NSAIDs should be avoided, and 1% atropine eye drops three times a day need to be instilled to prevent fibrinous reaction in the anterior chamber. If the eye becomes photophobic, a topical steroid (1% prednisolone acetate, 4-8 times a day) is to be considered, andIOP should be monitored. Surgical intervention is necessary when hyphema presents any of the following characteristics (Read’s criteria) [9]:
1. Corneal blood staining (corneal apoplexy)
2. Total hyphema with IOP equal to or greater than 50 mmHg for 5 days
3. Initially total hyphema that does not reduce below 50% with an IOP equal to or greater than 25 mmHg six days after the traumatic event
4. Hyphema that remains unresolved for 9 days
This surgical approach consists of removing any clots and washing out the anterior chamber [10]. (Figure 1)
A closed globe trauma affecting the anterior segment can result in various alterations, depending on their location. These can include:
• Radial tears of the iris sphincter
• Iridodialysis
• Angle recession
• Cyclodialysis
• Trabecular meshwork tears

• Lens subluxation or dislocation
• Traumatic cataract
• Phacoanaphylactic uveitis
• Phacolytic glaucoma
Lens injuries occur in 7-50% of eyes that have experienced significant ocular trauma. Besides a traumatic cataract, there can be lens subluxation or dislocation into the vitreous chamber [11]. In the case of lens subluxation, it is important to assess the extent of zonular weakness for appropriate surgical management. Particularly, if the zonular damage extends from 3 to 6 clock hours or less but is associated with pseudoexfoliation syndrome, Marfan syndrome, or similar conditions, the use of a capsular tension ring is highly recommended. Additionally, for a subluxated lens, trypan blue can be used to reduce the elasticity of the anterior capsule, facilitating the opening and propagation of the capsulorhexis. It is advisable to initiate the capsulorhexis in the direction of the damaged zonular fibers to avoid further stress and propagation of zonular damage [12]
Closed globe traumas affecting the posterior segment are more challenging to manage due to difficulties in visualization and poor functional prognosis. Depending on the location, they can include:
• Retinal contusion (Berlin’s edema)
Choroidal rupture
• Traumatic retinochoroidopathy
• Optic nerve avulsion
• Suprachoroidal hemorrhage (Figure 2)
• Retinal tears
• Retinal dialysis
• Retinal detachment
• Traumatic macular hole
In the case of post-traumatic retinal tears, they occur in 60% of cases near the ora serrata. For

a proper differential diagnosis, it is crucial to distinguish between retinal dialysis and giant retinal tears. Specifically, retinal dialysis is a retinal disinsertion from the pars plana to the ora serrata, typically with the vitreous base remaining attached to the posterior edge of the tear. These tears occur immediately after trauma and progress slowly towards retinal detachment due to the tamponade effect of the vitreous[13]. Post-traumatic retinal dialysis most commonly occurs in the inferotemporal sector, and their correct management involves episcleral surgery, as the vitreous base attached to the posterior edge of the dialysis acts as a tamponade, with no inverted flap or traction present. In contrast, giant retinal tears are almost always associated with posterior vitreous detachment. The vitreous remains attached only to the anterior flap of the retina, allowing free mobility of the posterior flap, which facilitates the ingress of liquefied vitreous into the subretinal space and leads to rapid progression of retinal detachment [14]. The proper management of a giant retinal tear associated with retinal detachment involves vitrectomy, which allows the removal of liquefied vitreous, reattachment of the retina, and introduction of a tamponade agent into the vitreous chamber (Figure 2).
A condition often associated with other ocular alterations found in closed globe trauma is a traumatic macular hole. By definition, a traumatic macular hole is a full-thickness defect of the neurosensory retina at the fovea, occurring after blunt eye trauma. Patients are generally young males between 20 and 30 years old, with the incidence of macular holes being 1.4% in closed globe traumas [15]. Small traumatic macular holes (<250 microns) have a higher likelihood of spontaneous resolution (the spontaneous closure rate is 50% in children and 28.6% in adults), typically occurring after a median of 5.6 weeks and within the first 3-6 months following trauma. Therefore, in cases of traumatic macular hole in young patients with good visual acuity, not complicated by other severe ocular injuries and with vitreous adhesion to
the posterior edges of the hole, clinical observation is strongly recommended. Surgical intervention should not be taken into consideration until at least 3 months after the traumatic event.
When dealing with a patient who has sustained an open globe ocular trauma, it is crucial to differentiate between a globe rupture and a laceration. A rupture involves a strong impact from a blunt object on the ocular wall, leading to the deformation of the globe. The fluid inside the eye is incompressible, causing a rapid and violent increase of the intraocular pressure. If the pressure is high enough or the ocular wall is sufficiently weak, an outward force creates a rupture at the weakest point of the ocular wall. The intraocular contents often extrude due to the direction and force of the energy, frequently with devastating effects. A laceration, on the other hand, is a breach of the ocular wall caused by a sharp object[16]. Depending on the mechanism of injury, the vector forces generated are typically less than those seen with blunt objects, resulting in a smaller increase in intraocular pressure and often less extrusion of intraocular contents. Lacerations are further classified into penetrating and perforating injuries. Penetrating injury, means that a sharp object entered and exited the eye through the same wound (e.g., a cut). In a perforating injury, there are separate entry and exit wounds, indicating that the same sharp object entered the eye at one point and had enough momentum to exit through a different point. If the object causing the wound enters and remains inside the eye, it is classified as a penetrating injury with retention of an intraocular foreign body. The primary goals of repairing an open globe injury, whether it is a rupture, penetration, or perforation, are to:
1. Close the globe with minimal tissue manipulation.
2. Reposition or remove exposed ocular tissue.
3. Identify any unknown injuries.
4. Reduce the risk of endophthalmitis and maximize the chances of functional recovery by restoring ocular integrity.
Small, self-sealing, clean corneal lacerations without iris incarceration or other ocular injuries can be closed with cyanoacrylate glue. Larger or more complex lacerations require surgical treatment, which involves the following steps [17-18] (Figure 3):
• Creation of a limbal paracentesis site.
• Injection of viscoelastic (preferably cohesive) into the anterior chamber to stabilize it, visco-separate the incarcerated iris from the wound, and protect the corneal endothelium and lens.
• If the uveal tissue appears necrotic or cannot be easily repositioned, excision may be necessary.
• For corneal lacerations, 10-0 Nylon sutures are recommended, starting with a central suture, and attempting to halve the wound with each subsequent suture.
Scleral wounds should be tackled with higher degree of suspicion for more extensive alterations of the ocular anatomy and prolapse of intraocular contents. It is crucial to identify the posterior margin of the lesion (if necessary, dissecting the conjunctiva and Tenon’s capsule with forceps and Westcott scissors to fully visualize the posterior extent of the scleral laceration) and to use thicker sutures than those used for corneal lacerations (Nylon 8-0 or 9-0) [18]. Often, large scleral lacerations present a significant prolapse of uveal tissue, making it difficult to close the wound. In such cases, placing one or two central sutures can stabilize the wound and allow for a more controlled repositioning of the prolapsed uveal contents. The surgical approach to a globe rupture is similar to the repair of corneal and scleral lac-


erations. Generally, ruptures are technically more challenging to repair, as the wound often has stellate edges and there is frequently significant loss of intraocular contents. Proper visualization of the rupture area is important, requiring a careful conjunctival peritomy and scleral hemostasis. The choice of suture can vary depending on the size of the wound, the tissue loss, and the location of the rupture; typically, interrupted Nylon 8-0 or 9-0 sutures are preferred. Rupture sites usually occur at the weakest point of the sclera, most commonly just posterior to the rectus muscle insertions. Other common sites of globe rupture include areas of previous ocular surgeries, especially cataract surgery or penetrating keratoplasty. A globe rupture can sometimes go undetected if associated with significant deep conjunctival chemosis, known as “jelly-roll” chemosis (Figure 5). Therefore, in a patient with ocular trauma and suspected globe rupture with deep conjunctival chemosis, scleral exploration in the operating room should always be performed [19]
Penetrating ocular trauma with a retained foreign body is one of the most challenging and dramatic events to manage. An intraocular foreign body is present in 20-40% of penetrating ocular injuries. Diagnosis requires a detailed history and clinical examination, and radiological investigation is often necessary to confirm the diagnosis. Once the diagnosis is confirmed, management varies depending on the location of the foreign body and the concomitant ocular injury. The composition of the foreign body is most often metallic, ranging from 86% to 96% according to many clinical studies. There is a strong predilection for these injuries to occur in young male workers [20]. A foreign body can enter the eye mainly due to its small size, sharp edges, and high velocity. Small, sharp objects penetrate the eye at high speeds, causing minimal damage to the surrounding tissues.
Slit lamp examination and fundus examination are essential diagnostic tools. A visible defect in the sclera, cornea, iris, or lens capsule with the visualization of a foreign body can confirm

the diagnosis. However, scleral wounds are often obscured by subconjunctival hemorrhage, and fundus examination can be hindered by the presence of vitreous hemorrhage. Therefore, the presence of an intraocular foreign body should always be considered in the context of a penetrating injury until proven otherwise. Transillumination is used to detect iris and lens capsule defects and should ideally be performed both before (for iris defects) and after (for lens capsule defects) pupil dilation. If there is severe disruption of the ocular wall, manipulation of the eye is not recommended until ocular anatomy is surgically stabilized. In such cases, a partial clinical examination is performed, the eye is protected with a shield or bandage, and auxiliary examinations are conducted to confirm the diagnosis and proceed with surgical intervention. Auxiliary tests are crucial to evaluate and confirm the diagnosis; if the mechanism of the injury is suspicious and the examination is inconclusive, imaging studies should always be obtained to rule out the presence of an intraocular foreign body. The current cornerstones for localizing a foreign body are computed tomography (CT) and ultrasound. Ultrasonography is operator-dependent; ultrasound tends to overestimate the size of a foreign body, and artifact echoes can often be misinterpreted as a foreign body. These issues do not occur with CT, which allows for a definitive diagnosis and precise localization of an intraocular foreign body.
The clinical management of an intraocular foreign body is complex and multifaceted, varying depending on the location of the foreign body. However, four main objectives are always pursued[21]:
1. Restore normal ocular anatomy
2. Prevent infections
3. Preserve vision
4. Prevent long-term sequelae
Tetanus prophylaxis is administered if not already in place. Most surgeons prefer to start with systemic antibiotic prophylaxis immediately. Anterior chamber foreign bodies account for

approximately 25-33% of all intraocular foreign bodies and are technically less challenging to remove compared to those located posteriorly. The surgical approach involves several steps:
• Cleaning the entry wound and repositioning any prolapsed uveal tissue
• Closing the wound with 10-0 Nylon sutures
• Performing a limbal paracentesis at different degrees relative to the foreign body’s location
• Introducing viscoelastic into the anterior chamber to maintain chamber depth and protect both the corneal endothelium and the anterior lens capsule
• Viscoelastic may be used to safely manipulate and displace small foreign bodies
• Removing the foreign body with forceps
Posteriorly located foreign bodies (Figure 6) represent the vast majority of intraocular foreign bodies and are challenging to manage, as they require an experienced vitreoretinal surgeon. These cases are generally associated with a poor functional prognosis, although advances in technology have slightly improved their outcomes compared to the past [22]
References
[1] Tielsch JM, Parver L, Shankar B. Time trends in the incidence of hospitalized ocular trauma. Arch Ophthalmol 1989;107: 519–523.
[2] Wong TY, Klein BEK, Klein R, et al. The prevalence and 5-year incidence of ocular trauma, the Beaver Dam Eye Study. Ophthalmology 2000;107:2196–2202.
[3] May DR, Kuhn FP, Morris RE, et al. The epidemiology of serious eye injuries from the United States Eye Injury Registry. Graefe’s Arch Clin Exp Ophthalmol 2000:238:153–157.
[4] Bae E, Messman A, ShahK. Ocular Injuries: emergency department strategies. Emergency medicine practice 2023; 25(Suppl 10):1-38.
[5] Baker RS, Wilson MR, Flowers CW, et al. A population-based survey of hospitalized work-related ocular injury: diagnoses, cause of injury, resource utilization, and hospitalization outcome. Ophthalmic Epidemiol 1999;6:159–169.
[6] Ostadian F, Farrahi F, Zolfaghari M, et al. Analysis of Operated Patients with Ocular trauma: A 10-Year retrospective Study. Advenced biomedical research 2023:12:64
[7] Liu X, Wang L, Wang C, et al. Mechanism of traumatic retinal detachment in blunt impact: a finite element study. Journal of Biomechanics 2013; 46(7):1321-7.
[8] Pieramici DJ, Sternberg P Jr, Aaberg TM Sr, et al. A system for classifying mechanical injuries of the eye (globe). The Ocular Trauma Classification Group. American journal of ophthalmology 1997; 123(6):820-31.
[9] Read J E, Goldberg M F. Blunt ocular trauma and hyphema. International ophthalmology clinics 1974;14(4):57-97.
[10] Walton W, Von Hagen S, Grigorian R, et al. Management of traumatic hyphema. Survey of Ophthalmology 2002; 47(4):297-334.
[11] Mehul S, Shreya S, Pramod U, et al. Controversies in traumatic cataract classification and management: a review. Canadian journal of ophthalmology 2013; 48(4):251-8.
[12] Agarwal A, Kumar DA, Nair V. Cataract surgery in the setting of trauma. Current opinion in ophthalmology 2010; 21(1):65-70.
[13] Hamrick KE, Helgeson MK. Retinal dialysis. Optometry clinic: the official puclication of the Prentice Society 1992;2(3):93-112.
[14] Hoogewoud F, Chronopoulos A, Varga Z, Souteyrand G, Thumann G, et al. Traumatic retinal detachment—the difficulty and importance of correct diagnosis. Survey of Ophthalmology 2016; 61(2):156-63.
[15] Budoff G, Bhagat N, Zerbin MA. Traumatic Macular hole: Diagnosis, Natural History, and Management. Journal of Ophthalmology 2019:5837832.
[16] Kuhn F, Morris R, Witherspoon CD. Birmingham Eye Trauma Terminology (BETT): terminology and classification of mechanical eye injuries. Ophthalmol Clin North Am 2002;15(2):139–143.
[17] Vora GK, Haddadin R, Chodosh J. Management of corneal lacerations and perforations. International ophthalmology clinics 2013; 53(4):1-10.
[18] M Bowes Hamill. Corneal and scleral trauma. Ophthalmology clinics of North America 2002;15(2):185-94.
[19] Chronopoulos A, Ong JM, Thurmann G, James S Schutz. Occult globe rupture: diagnostic and treatment challenge. Survey of Ophthalmology 2018; 63(5):694-699.
[20] Loporchio D., Mukkamala L, Gorukanti K, Zerbin M, Langer P, et al. Intraocular foreign bodies: A review. Survey of ophthalmology 2016;61(5):582-96.
[21] Parke DW 3rd, Flynn HW Jr, Fischer YL. Management of intraocular foreign bodies: a clinical flight plan. Canadian journal of ophthalmology 2013;48(1):8-12.
[22] Liu X, Ji MM, Jon L, Zeng AP. Microsurgical Vitrectomy with Pars Plana Incision for the Removal of Posterior Segment Intraocular Foreign Bodies. Journal of Ophthalmology 2024:3270197
Francesco Semeraro
Systemic vascular disorders like hypertension, vascular occlusions, embolic disease, blood dyscrasias and sickle cell disease can affect the eye. Ophthalmologists often play a crucial role in the early diagnosis and management of patients with systemic vascular and circulatory disease.
Systemic hypertension is categorised in 3 stages: elevated blood pressure (120-129/<80 mmHg), stage 1 hypertension (130-139/80-89 mmHg) and stage 2 hypertension (≥140/ ≥90 mmHg). Systemic hypertension affects several organ systems, including the cardiovascular system, kidneys, and the central nervous system. Similarly, the eye is a primary target of systemic hypertension, potentially impacting the retina, choroid, and optic nerve.
Hypertensive retinopathy: the three most important pathogenetic aspects of hypertensive retinopathy are vasoconstriction, alteration of permeability and arteriosclerosis. Narrowing (vasoconstriction) is the initial response of the retinal arterioles to hypertension. Obstruction of the precapillary arterioles causes ischemic damage to the retinal nerve fibre layer (RNFL), resulting in the formation of cotton-wool spots. In chronic hypertension damage to the retinal blood-barrier causes abnormal permeability, leading to the formation of haemorrhages, hard exudates, and retinal oedema. Arteriosclerosis causes thickening of the arteriolar wall and manifests with arteriovenous nicking at crossing points.
Malignant hypertension is an acute medical emergency (diastolic blood pressure ≥120 mmHg). This condition must be recognized and controlled to minimise hypertensive encephalopathy, heart, and renal failure. Patients with malignant hypertension may present to the ophthalmologist due to blurred vision. Ocular findings include optic disc oedema and, occasionally macular oedema with flame-shaped haemorrhages. [1-5]
Retinal Vein Occlusion: systemic hypertension is a possible cause of both central (CRVO) and branch retinal vein occlusion (BRVO).
CRVO: it is caused by obstruction of the venous outflow, possibly at or posterior to the lamina cribrosa. It manifests with sudden, painless and severe monocular vision loss. Fundus appearance is characterised by optic disc and macular oedema, many scattered flame-shaped and dot-and-blot haemorrhages and severe tortuosity of the vessels. Neovascularization of the iris (NVI) is common (up to 60%) and can lead to neovascular glaucoma (NVG).
In BRVO occlusion commonly occurs at a site of arteriovenous crossing. Because arterioles and veins share the same adventitial sheath at arteriovenous crossings, it is thought that a thickened artery compresses the underlying vein. BRVO is characterised by a sudden, painless onset of monocular blurred vision. Clinical signs include tortuosity of the affected venous segment, flame-shaped and dot-and-blot haemorrhages, cotton-wool spots, and retinal
oedema in the territory of the affected vessel. NVI and NVG are less common in BRVO than in CRVO. [6-8]
An embolus is a free clot that travels through the bloodstream and can obstruct blood flow. Arterial embolism starting from the heart or the carotid can also affect the eye. Retinal emboli can originate from cardiac sources due to various causes, including valvular lesions, patent foramen ovale, and left atrial myxoma. However, the source of embolic material in the retinal circulation is more commonly an atheromatous plaque in the carotid artery. In rare cases, embolization may also be caused by infective endocarditis, long bone fracture (fat embolism) and intravenous drugs. The 3 most common types of emboli are cholesterol (Hollenhorst plaques), platelet-fibrin, and calcium.
It is believed that most retinal artery occlusions are caused by atherosclerosis related embolism.
In Central retinal artery Occlusion (CRAO) the patient experiences a sudden, severe, and painless vision loss. Visual acuity is usually severely compromised, except in cases where a cilioretinal artery supplies the macula. Fundus examination shows oedematous retina except for a “cherry red-spot” due to preserved choroid supply in the fovea. Emboli are visible in 20% of cases, but retinal oedema may take several hours to develop. The prevalence of ocular neovascularization after CRAO ranges between 2.5% and 31.6%.
Branch retinal artery occlusion (BRAO) is characterised by sudden sectoral or altitudinal vision loss, a pale and oedematous retina in the area supplied by the obstructed blood vessel, and attenuation of the arteries with segmentation of the blood column. Emboli may sometimes be observed, particularly at bifurcations. The affected artery may recanalize leaving no signs of prior occlusion.
The term Amaurosis Fugax typically refers to a transient vision loss (TVL) secondary to transient acute retinal ischemia. The most common cause of Amaurosis Fugax is carotid artery disease with secondary thromboembolism, followed by embolism of cardiac origin. Many other causes are reported in literature, including hypercoagulable states, retinal migraine, Takayasu’s arteritis and antiphospholipid syndrome.
Visual loss usually lasts for a few minutes, and the fundus examination is usually normal. Since Amaurosis Fugax can be a sign of an ipsilateral cerebral transient ischemic attack (TIA) with contralateral neurological signs, the examiner must undertake a careful investigation and management due to the higher risk of cerebral stroke. [9,10]
Migraine is a primary headache disorder characterised by recurrent, severe, and often debilitating unilateral headaches associated with autonomic symptoms. It can be preceded by or accompanied by neurological and mood disorders. Studies on the pathophysiology of migraine suggest a role of the vascular system correlated to activation of trigeminal fibres. The most common neuro-ophthalmic symptoms are photophobia and visual aura. In migraine with aura (classical migraine), the attack is preceded by neuro-ophthalmological symptoms that are commonly visual and binocular. Initially, a negative binocular scotoma occurs, followed by positive phenomena consisting in scintillating scotoma with fortification spectrum or, less commonly, tunnel vision. However, positive symptoms may not always occur, and patients might also report that the scotoma lacks colours. When positive features are present, they remain visible even with closed eyes. The aura usually resolves completely within 60 minutes.
In Migraine aura without headache, patients experience only visual symptoms without headache. Typical aura without migraine must be differentiated from cerebral TIA and occipital lobe seizure, especially when negative phenomena like hemianopia are predominant, when the duration is atypical, or when the first episode occurs after the age 40.
Retinal migraine is a controversial entity that is characterised by migraine headache and reversible monocular vision loss, scotomas, scintillation, or blindness. Other causes of transient monocular vision loss like TIA must be excluded.
Ophthalmoplegic migraine usually begins in children, and its main feature is recurrent migraine attacks followed by cranial nerve palsy. The third cranial nerve is the most affected. [11-13]
Hyperviscosity syndromes are a group of disorders characterised by an increase in blood viscosity due to an elevated number of red blood cells, white blood cells, or plasma proteins, as seen in polycythaemia, leukaemia and macroglobulinemia, respectively. The clinical presentation of HVS involved mainly neurological and visual symptoms and mucosal bleeding. Neurological symptoms may include dizziness, paraesthesia, ataxia, headache, and seizure, while visual changes can range from blurred vision to vision loss. In the eye, blood alterations lead to retinal manifestations like increased vascular tortuosity and haemorrhages and exudates. Haematological changes are a significant risk factor for venous occlusion (particularly CRVO). [14] Leukemias are a group of haematological malignancies related to white blood cells, caused by anomalies of hematopoietic stem cells that replace the normal bone marrow. Ocular manifestations of leukaemia are common, and involvement of every ocular structure has been described.
Ocular manifestations may be related to haematological changes, leukemic infiltration, or opportunistic infections. Clinically, the retina is the most affected structure: leukemic retinopathy is caused by the hematologic abnormalities and manifest as increased tortuosity of retina vessels, retinal and preretinal haemorrhages, hard exudates, cotton-wool spots, and white centred haemorrhages. Retinal leukemic infiltrates appear as retinal or subretinal yellow deposits. Vitreous involvement is rare while choroid involvement may be hard to identify. Anterior segment involvement includes comma-shaped conjunctival vessels, iris infiltration, pseudohypopyon, and hyphema. Leukemic infiltration of the optic nerve may be characterised by severe optic nerve edema that requires immediate treatment and systemic assessment since it may indicate central nervous system involvement. [15]
Sickle-cell disease is a group of genetic disorders caused by the presence of a mutant form of haemoglobin (HbS). Anaemia is chronic and haemolytic. Red blood cells in patients with sickle-cell disease assume abnormal shapes under some conditions such as hypoxia and acidosis, leading to obstruction of small vessels and tissue ischemia. Vaso-occlusive crisis, marked with severe pain, are the most common manifestation of SCD. Sickle-cell retinopathy can be classified into non-proliferative and proliferative. The non-proliferative form is usually asymptomatic. Ocular findings include increased vessel tortuosity, peripheral retinal haemorrhages (salmon patch), peripheral chorioretinal atrophy (black sunburst), peripheral refractive spots of hemosiderin and silver wiring of vessels. In proliferative sickle cell anaemia, vascular occlusion and ischemia lead to peripheric “sea fan” neovascularization, vitreous haemorrhage, and tractional retinal detachment. Peripheral neovascularization can be treated with laser panphotocoagulation and vitrectomy, if necessary.
Non-retinal manifestations include ischaemic iris atrophy, rubeosis and corkscrew-shaped conjunctival vessels. [16,17]
Congenital Conditions
Several congenital syndromes are characterised by ocular manifestations. The ophthalmologist can detect ocular conditions or subtle details that help establish a diagnosis. We will focus on Marfan syndrome and Neurofibromatosis.
Marfan syndrome
Marfan syndrome (MFS) is an autosomal dominant genetic disorder characterised by the weakening of connective tissue in various organs due to a defective fibrillin-1 (FBN1) protein on chromosome 15, which is a structural component of microfibrils found in connective tissue. MFS has variable expressivity, and no signs considered pathognomonic; however the cardiovascular, skeletal, and ocular systems are the most commonly involved.
The most significant ocular feature in Marfan syndrome is ectopia lentis which is typically bilateral, non-progressive and located in the superotemporal quadrant. Patients also have an increased risk of retinal detachment because of high incidence of high myopia, lattice degeneration, vitreous traction from ectopia lentis and thinning of the sclera and choroid. Other ocular manifestations include cornea plana, microspherophakia, and glaucoma. [18,19]
Neurofibromatosis
Phacomatosesare a wide group of congenital disorders characterised by hamartomatous lesions affecting the skin, eye, and central and peripheral nervous system. The most common form of phakomatosis is neurofibromatosis. There are two distinct types described: Neurofibromatosis type 1 (NF1) and neurofibromatosis type 2 (NF2). NF1 is the most common (1:2500) and it is autosomal dominant with complete penetrance. Ocular manifestations are much more common in NF1 than NF2. In NF1 mutation of tumour suppressor Neurofibromin, product of gene NF1, leads to uncontrolled cellular proliferation. NF1 is characterised by neural tumours affecting the nervous systems and the adrenal gland (pheochromocytoma). Caféau lait spots, which appears at birth, are typical, while skeletal defects may involve the greater wing of the sphenoid causing proptosis. [20]
Lisch nodules are the most common ocular features in NF1, consisting of asymptomatic melanocytic hamartomas that usually appear as small, dark brown nodules on the iris. their prevalence rises in late childhood, reaching 100% in adults over the age of 21. [21] Others important ocular manifestations include optic nerve or visual pathway gliomas, plexiform neurofibromas infiltrating the orbit or the eyelids, choroidal hamartoma, and retinal tumours. It is recommended that children with NF1 undergo regular ophthalmic follow-ups to monitor visual acuity, visual fields, and colour vision. [22]
AIDS is the terminal stage of infection caused by human immunodeficiency virus (HIV). The most severe systemic complications occur with very low CD4 levels (<50 cell/ml) in advanced stage disease. AIDS may be responsible for a large range of ocular manifestations. The most common finding is AIDS-related microangiopathy (non-infectious) and it is characterised by microaneurysms, retinal haemorrhages, and cotton-wool spots. Herpes zoster ophthalmicus can develop in HIV-positive patients, and the associated keratouveitis is usually severe. [23] The most common opportunistic infection involving the eye in AIDS patients is cytomegalovirus (CMV) retinitis. This condition is often bilateral and indicates severe immunodeficiency.
The advent of HAART (Highly Active Antiretroviral Therapy) has greatly reduced the incidence of CMV retinitis in AIDS patients. However CMV remains the most common cause of opportunistic ocular infection in HIV patients with CD4 lymphocytopenia. [24]

Intraocular tumours encompass a wide spectrum of both benign and malignant lesions. Intraocular metastasis is the most common intraocular malignancy and frequently the first sign of tumour spread. Since the mechanism of intraocular metastases is based on hematogenous dissemination, the uvea is the most affected site. Uveal metastases involve the choroid in approximately 88% of cases, less frequently the iris (9%) and the ciliary body (2%) whereas the retina and vitreous are rarely affected. [25]
Metastatic carcinoma is the most common type of intraocular metastatic tumour, with the breast and the lung being the most common primary site. Choroidal metastases are often located posterior to the equator and appear as single or multiple creamy-white or pale-yellow masses associated with subretinal fluid. They can be flat, plateau-like, or rarely, mushroom shaped and are sometimes accompanied by clumps of brown pigment (“leopard spots”). One or both eyes may be affected. Carcinomatous metastases to the iris and ciliary body appear as white-grey or amelanotic nodules and may be associated with iridocyclitis, hyphema and secondary glaucoma. Treatment options include local radiation therapy and chemotherapy. Prognosis is poor for patients with intraocular metastasis, with the median survival of 6 months following the diagnosis of choroidal metastasis. [26,27]
Autoimmunity refers to a body’s reaction against its own components. Many systemic autoimmune conditions affect the eye (e.g., rheumatoid arthritis, lupus erythematosus, ankylosing spondylitis etc.), and in some cases, the eye is the only organ involved (e.g., ocular cicatricial pemphigoid, Mooren’s corneal ulcer and various forms of uveitis). Patients may report symptoms like dry eye, pruritus, photophobia, visual changes etc. Inflammation can affect any part of the eye, including the cornea, retina, uveal tract, and sclera. Typically, managing the
systemic disease with corticosteroids or other immunosuppressive agents helps control ocular signs, but in some cases, specific ophthalmic therapies are required d. For patients with suspected autoimmune conditions, early referral to an ophthalmologist is crucial to prevent ocular disabilities. [28,29]
It includes a large number of disorders affecting skin, fat, muscles, joints, tendons, ligaments, bones, cartilage, and even the eye, blood, and blood vessels. Some of these are autoimmune conditions (comprehending rheumatoid arthritis, Systemic Lupus erythematosus, periarteritis nodosa etc.). Many ocular complications of these conditions are well known, such as keratitis, scleritis, retinal vasculitis etc. In the next paragraphs, we will review the main ocular manifestations of these disorders.[30]
Rheumatoid arthritis (RA) is a chronic inflammatory disease of unknown etiology characterised by symmetrical flogosis of articulations. Most patients are positive for rheumatoid factor (IgM). There are many extra ocular manifestations, including subcutaneous nodules, Felty’s syndrome (splenomegaly, thrombocytopenia, leucopenia), pleural effusion, and vasculitis. The primary ocular manifestation is keratoconjunctivitis sicca secondary to fibrosis of the lacrimal glands. Sometimes RA may cause episcleritis and scleritis. Primary Keratitis affects 2% of patients in the form of peripheral corneal guttering, which is characterised by progressive thinning of peripheral cornea or keratolysis, an acute and severe corneal melting. Uveitis may occur in some patients. Rheumatoid retinal vasculitis is a rare and late manifestation. [31-34]
Ankylosing Spondylitis (AS): it is an inflammatory arthritis involving the axial skeleton, characterised by progressive ankylosis of articular capsules and tendons. Patients are often male, between the ages of 30 and 40 years old and are positive for HLA B27 haplotype. They present with back pain due to sacroiliitis, spinal involvement with bony ankylosis and peripheral arthropathy. Other manifestations may include aortitis, chronic prostatitis, and lung fibrosis.
Acute recurrent anterior uveitis
Both eyes involved usually alternatively
Iridous-lenticular synechiae
Aqueous humor cellularity and flare
Sterile hypopion
Small gray endothelial deposits
About 25% of patients develop recurrent acute iridocyclitis, with no correlation with systemic arthritis. Patients with HLA B27 haplotype tend to have a worse prognosis. Rarely, AS patients may develop scleritis, episcleritis, and keratitis. Posterior segment involvement is uncommon. Most common findings include vitritis and papillitis. Rare manifestations include retinal vasculitis, pars plana exudates, and cystoid macular edema. [33,35,36,37]
Systemic Lupus Erythematous (SLE) is a systemic autoimmune disorder characterised by tissue and organ damage mediated by immune complex deposition and other antibody related mechanisms, vasculitis and thrombosis. SLE is nine times more prevalent in women of Asian and African descent during their reproductive years. About one third of patients experience ocular manifestation, the most common of which is keratoconjunctivitis sicca. Clinical features include ocular discomfort, exposure keratopathy and, in some cases, consequent corneal scarring, ulceration and filamentary keratitis. Other anterior manifestations are periph-
eral ulcerative keratitis (PUK), scleritis and episcleritis. Uveitis is rare. Severe vasoocclusive retinopathy is present in up to 29% of patients, initially presenting with haemorrhages and cotton wool spots. As the disease progresses, vascular occlusion may develop, together with retinal ischemia and neovascularization. SLE retinopathy has a poor visual prognosis and is associated with the systemic progression of the disease. Rare ocular manifestations include orbital vasculitis, myositis, and panniculitis, as well as optic neuritis, anterior and posterior ischemic optic neuropathy, and cortical infarcts. [38-40]
Polyarteritis Nodosa (PAN): It is a rare idiopathic disorder characterised by necrotizing arteritis of small and medium-sized vessels. This leads to thrombosis, aneurysms formation and, consequently, tissue damage and injury to various organs. The clinical presentation includes subacute onset of muscular-skeletal and abdominal pain, anorexia, weight loss, fever, skin lesions arthritis and arthralgia. Renal involvement is quite common, as is mesenteric infarction. Peripheral nerve involvement (mononeuritis) and cardiopulmonary complications may also occur.. Ocular complications, though rare, can be devastating. PAN may cause a bilateral progressive necrotizing peripheral ulcerative keratitis, which is usually resistant to topical therapy. It usually spreads circumferentially but may also extend centrally, often accompanied by necrotizing scleritis. Ischemic retinopathy may develop as central or branch retinal arteries occlusion. Rarely an anterior ischemic optic neuropathy may occur. [41,43]
Sarcoidosis: is a multisystem disorder characterised by non-caseating granulomas in the lungs and other organs. In 90-95% of cases, the lungs are primarily involved (four stages starting from hilar lymphadenopathy to progressive pulmonary fibrosis). Patients often report dyspnoea, cough, and systemic symptoms like malaise, arthralgia. Sarcoidosis may lead to skin lesions (erythema nodosum) cardiomyopathy and arrhythmias, renal and liver diseases, central nervous system disorders (peripheral neuropathy, cranial nerve palsies). Ocular involvement occurs in 25-70% of patients, with or without systemic symptoms. In two-thirds of cases, only the anterior segment is involved as acute (AAU) or chronic (CAU) uveitis. The International Workshop on Ocular Sarcoidosis (IWOS) identified 7 typical features of sarcoid uveitis: 1. endothelial precipitates (mutton fat like deposits) and irideal nodules (Koeppe and Busacca), 2. Trabecular meshwork, 3. Vitreal opacities, 4. Corio-retinal lesions, 5. Periflebitis en taches de bougie, 6. Optic disc granulomas, 7 Bilateral involvement. Sometimes purple sarcoid plaques (lupus pernio) may appear on the eyelid, and conjunctival granulomas or involvement of the lacrimal glands can lead to keratoconjunctivitis. Retinal vasculitis occurs in 7% of patients with chronic sarcoidosis and in 25% with ocular manifestations. It is characterised by periphlebitis appearing as candle-wax drippings, retinal and choroidal neovascularization. Vitreitis (characterised by vitreal opacities like cotton balls and string of pearls), choroidal and optic nerve granulomas may also occur. [44,45]
Giant cell arteritis (GCA): Is an idiopathic necrotizing vasculitis affecting large and medium-sized arteries composed of highly elastic tissue like superficial temporal, ophthalmic, vertebral, posterior ciliary and aortic. The typical presentation occurs between the seventh and eighth decades of life, with women being four times more affected than men. Clinically, it presents with headache, scalp tenderness, jaw claudication, and systemic symptoms (weight loss, anorexia, fever etc). Some patients may also experience polymyalgia rheumatica. In some cases, the disease manifests with sudden blindness caused by Anterior Optic Disk Ischemia (AION). This is the most frequent complication caused by arteritic occlusion of posterior ciliary arteries. AION usually occurs a few weeks after other symptoms appear, but in 20% of cases, it is the first clinical sign of the GCA. Patients report profound visual loss, sometimes with diplopia, periocular pain, flashing lights. Although both eyes can be affected, this usually does not happen simultaneously. Visual loss is often permanent. Fundus examination may
reveal a swollen optic nerve head, small splinter-shaped peripapillary haemorrhages. Within 1-2 months, the optic disc becomes pale. [46,47]
Thyroid autoimmune disorders. The Graves-Basedow disease is one of the most common autoimmune conditions affecting the thyroid gland. It is caused by the production of anti TSH antibodies (TSAb stimulating antibodies and TBII blocking antibodies) that alter thyroid hormone production. In most cases, this results in overproduction of thyroid hormones (hyperthyroidism). Patients usually report irritability, tachycardia, weakness, weight loss, diarrhoea etc. Occasionally ophthalmopathy may occur with or without thyroid dysfunction. It is primarily caused by inflammation of the soft tissue within the orbit and subsequent deposition of mucopolysaccharides and connective tissue. Clinically, it is characterised by eyelid signs (lid retraction or Dalrymple’s sign, lid lag or Von Graefe’s sign, infrequent blinking, fine tremor on lid closure) and infiltrative signs (proptosis, retractive myopathy, chemosis, superior limbic keratoconjunctivitis and, in some cases, optic neuropathy). Patients often report ocular pain, epiphora, and diplopia. A Clinic Activity Scale (CAS) is used to assess disease activity. [48-50]
Myasthenia Gravis: It is an autoimmune disease characterised by weakness and fatigue of ocular, bulbar and skeletal muscles. It is caused by autoantibodies directed against the acetylcholine receptor, leading to defects in neuro-muscular transmission. It can be associated with other autoimmune conditions such as RA, SLE, Sjogren disease etc. Patients report difficulty with chewing and swallowing, limb weakness, and ocular disturbs. Ocular involvement is present in approximately 90% of cases, presenting the characteristic in 90% of patients. Ocular symptoms include bilateral but asymmetrical ptosis, occasional nystagmoid movements, and diplopia that is the more bothersome symptom for patients. Diplopia is frequently vertical but all eye muscles may be affected. [51]
Idiopathic disorders
Multiple Sclerosis: Multiple sclerosis (MS) is a chronic idiopathic inflammatory disease characterised by central nervous system (CNS) lesions that can result in physical and cognitive disability. The aetiology of MS is multifactorial, including environmental and genetic factors. In MS, the immune system attacks neurons, leading to cell death and demyelination of nerves that produce neuronal dysfunction. Clinical features depend on damage to the spinal cord (weakness, sensory disturbances, muscle spasm, autonomic defects affecting urinary, sexual and bowel functions) and CNS dysfunctions (ataxia, dysarthria, nystagmus etc). Many patients develop optic neuritis (which may represent clinical presentation of the disease). Patients typically report an acute onset of monocular vision loss associated with periocular pain. Usually, visual acuity improves within 4-6 weeks. They may also experience reduced sensitivity to light, impaired colour vision, and a relative afferent pupillary defect. In most cases, there is no visible sign on ophthalmoscopy, though optic disc edema may occasionally be observed. Patients may also develop internuclear ophthalmoplegia with defective adduction of the ipsilateral eye, ataxic nystagmus of the contralateral adducted eye, but normal convergence. Retinal vasculitis may occur rarely. [52,53]
Diabetes Mellitus: it is one of the most common conditions in developed countries. It is characterised by impaired glucose absorption due to either a defect in insulin production and/or reduced glucose sensitivity (glucose resistance). Acute high blood glucose levels are responsible for primary clinical symptoms (polydipsia, polyuria, nocturia) while chronic exposure to hyperglycemia is responsible for chronic complications like nephropathy, atherosclerosis, neuropathy, and diabetic retinopathy (DR). The latter is present in 25% of overall patients.
Principal risk factors for developing DR are the duration of diabetes and its metabolic control. DR is characterised by:
Microaneurysms
Dot- and-blot haemorrhages
Hard exudates
Diffuse and/or macular Edema
IRMA (Intraretinal Microvascular Abnormalities
Diffuse vascular alterations
In severe hypoxia, neovascularization may develop on or away from the optic disc, associated with the formation of white fibrous components. The condition is referred to as proliferative DR and requires urgent treatment.
In advanced cases, persistent vitreous haemorrhages, tractional retinal detachment and neovascular glaucoma with iris rubeosis may appear.
Diabetes is also responsible for early development of senile cataract. In some cases, a specific form is observed due to osmotic overhydration of the lens, presenting as bilateral, punctate or snowflake opacities. Oculomotor nerve palsies may occur, especially third (pupil sparing) nerve palsy (sometimes sixth and fourth may also be involved). Diabetics often report refractive changes mainly linked to glycemic hyperhydratation of the lens, which in turn causes a myopic shift. [54]
Ocular adverse effect of systemically administered drugs.
Many drugs used for systemic purposes can have toxic effects on the ocular system if used chronically (corneal deposits, dry eye complications, colour vision disturbances, optic nerve inflammation etc). The interaction between molecules complicates the spectrum of possible adverse events and it is not often possible to establish a clear cause-effect relationship. Ophthalmologists must consider the possible ocular side effects of systemic treatment to diagnose and properly manage certain ocular conditions. In this paragraph, we summarise the principal ocular side effects of drugs used for the most common systemic pathologies. Drugs affecting the autonomic nervous system: they are used to treat disorders like ADHD, oculogyric crisis, or enuresis in children. They affect the function of the ciliary body, iris, and lens, causing angle-closure glaucoma and accommodation difficulties (i.e. oxybutynin used for enuresis)
Drugs acting on Central Nervous System (CNS): psychotropic medications that cross the BBB may have different ophthalmic side effects. i.e. Phenothiazines, antipsychotic drugs, can cause keratoconjunctival disorders; in particular, chlorpromazine can alter corneal and conjunctival pigmentation, accelerate cataract development, and may cause retinopathy. Lithium, used to treat major depression, can lead to corneal deposits, dry eye syndrome, and may cause exophthalmos and papilledema. Antiepileptic medications may result in extraocular muscle palsies, nystagmus, blurred vision, and can alter CV. BDZ, a class of medication used mainly to treat anxiety and sleep disturbances, may induce acute angle-closure glaucoma and ocular movement disorders.
Drugs used for Cardiovascular System: anti-hypertensive formulations may affect the ocular system. Hydrochlorothiazide is a diuretic that may cause visual changes and yellowing of the
eye; B-blockers reduce tear secretion, causing ocular irritation, dry eye and intolerance to LAC. Amiodarone, an antiarrhythmic drug, may cause photo-sensitation, vortex keratopathy, maculopathy, and optic neuritis. Nitrates, which are used to treat angina, may cause angle-closure glaucoma- Losartan may cause cataract. HMG CoA reductase may cause ocular haemorrhages and lens opacities. Atorvastatin, in particular, may also cause dry eye, IOP increase, and ptosis.
Antidiabetics: Gltitazones may cause diabetic macular edema (DME), while insulin and sulfonylureas determine crystalline deposits, diplopia, optic neuritis, extraocular muscle palsies and myopia.
Hormones. Bisphosphonates, used for treating osteoporosis, can cause inferior-nasal nodular scleritis, blurred vision, and uveitis. Tamoxifen, is an antiestrogen used in the treatment of breast cancer, and can produce retinotoxicity characterised by multiple parafoveal deposits, EMC, and vortex keratopathy. Bilateral optic neuropathy was reported in a few cases.
NSAIDs: Non-steroidal anti-inflammatory drugs are widely used for many indications. Aspirin is one of the most used. Frequently it can cause dry eye and subconjunctival haemorrhages. Sometimes, when used in combination with warfarin, it may cause hyphema and retinal detachment. Ibuprofen in rare cases may determine centrocecal deficits and optic neuritis.
Steroids: Steroids are widely used to suppress chronic inflammatory processes and for replacement therapy. Chronic use of steroids may raise IOP, subcapsular cataract, mydriasis, and CRS. Cataract usually develops in patients receiving moderate to high maintenance doses over long periods. Initially, it manifests as posterior subcapsular opacity followed by anterior subcapsular. Early opacities may regress upon discontinuation of the medication, but progression can continue despite stopping the drug. Topical steroids may raise the IOP, though systemic therapies rarely cause this effect.
Antihistamines: they may induce dry eye, reduce accommodation, and increase IOP. Antimicrobial: different molecules have different side effects on the eye. Aminoglycosides can sometimes induce retinal toxicity, while fluoroquinolones may cause diplopia. Amphotericin B, used in the treatment of fungal infections, may cause CA inflammation and corneal defects. Etambutol, a drug used to treat tuberculosis, may cause optic neuropathy at a dose of 15 mg/ Kg. Clinical features include a profound and sudden decrease in VA, impaired colour vision, and sometimes alteration of optic disc (oedema, splinter-haemorrhages). Normally VA recovery occurs some months after discontinuation of the drug.
Antimalarials: Chloroquine and Hydroxicloroquine may cause corneal changes and maculopathy. The incidence of retinal damage is dose-dependent (the risk increases significantly when the cumulative dose exceeds 300g) and is more significant with chloroquine (hydroxychloroquine appears to be safer and, when retinal damage occurs, it is usually mild and non-progressive). Chloroquine maculopathy progresses through different stages: 1. Premaculopathy is characterised by a scotoma to a red target between 4° and 9° of fixation (reversible upon discontinuation); 2. Established maculopathy with slight reduction in visual acuity, disappearance of foveolar reflex, and the presence of parafoveal halo (non progressive if therapy is stopped) 3. Bull’s eye maculopathy, characterised by reduced VA, hyperpigmentation of fovea with a halo of depigmentation, and an external hyper pigmented circle (it may progress although therapy discontinuation); 4. Severe maculopathy, reduction in VA, macular pseudo-hole with surrounding area of EPR atrophy; 5. End stage maculopathy characterised by severe reduction of VS and ERP atrophy. Corneal vortex keratopathy is due to drug deposition into the corneal stroma. It is reversible upon cessation and rarely causes a slight reduction inVA.
Anticancer Drugs: Methotrexate and others chemotherapies may cause ocular irritation and cataract. [56]
References
1. Wong TY, Mitchell P. The eye in hypertension. Lancet. 2007 Feb 3;369(9559):425-35.
2. Kim SK, Mieler WF, Jakobiec F. Hypertension and its ocular manifestations. In: Albert DM, Miller JW, Azar DT,
3. Blodi BA, eds. Albert & Jakobiec’s Principles and Practice of Ophthalmology. 3rd ed. Philadelphia:Saunders; 2008:4367–4384.
4. Wong TY, Mitchell P. Hypertensive retinopathy. N Engl J Med. 2004 Nov 25;351(22):2310-7
5. Fraser-Bell S, Symes R, Vaze A. Hypertensive eye disease: a review. Clin Exp Ophthalmol. 2017 Jan;45(1):45-53 Epub 2017 Jan 21. PMID: 27990740.
6. Ho M, Liu DT, Lam DS, Jonas JB. RETINAL VEIN OCCLUSIONS, FROM BASICS TO THE LATEST TREATMENT. Retina. 2016 Mar;36(3):432-48.
7. Hayreh SS. Retinal vein occlusion. Indian J Ophthalmol. 1994 Sep;42(3):109-32. PMID: 7829175.
8. Blair K, Czyz CN. Central Retinal Vein Occlusion. 2020 May 23. In: StatPearls [Internet]. Treasure Island (FL): StatPearls Publishing; 2020 Jan–. PMID: 30252241.
9. Hayreh SS. Acute retinal arterial occlusive disorders. Prog Retin Eye Res. 2011 Sep;30(5):359-94 Varma DD, Cugati S, Lee AW, Chen CS. A review of central retinal artery occlusion: clinical presentation and management. Eye (Lond). 2013 Jun;27(6):68897.
10. Biousse V. Acute retinal arterial ischemia: an emergency often ignored. Am J Ophthalmol. 2014;157(6):1119–1121
11. Dodick DW. Migraine. Lancet. 2018 Mar 31;391(10127):1315-1330
12. Schwartz DP, Robbins MS. Primary headache disorders and neuro-ophthalmologic manifestations. Eye Brain. 2012 Sep 13;4:49-61.
13. Van Dongen RM, Haan J. Symptoms related to the visual system in migraine. F1000Res. 2019 Jul 30;8:F1000 Faculty Rev-1219
14. Perez Rogers A, Estes M. Hyperviscosity Syndrome. [Updated 2020 Aug 24]. In: StatPearls [Internet]. Treasure Island (FL): StatPearls Publishing; 2020 Jan-
15. Talcott KE, Garg RJ, Garg SJ. Ophthalmic manifestations of leukemia. Curr Opin Ophthalmol. 2016 Nov;27(6):545-551.
16. Elagouz M, Jyothi S, Gupta B, Sivaprasad S. Sickle cell disease and the eye: old and new concepts. Surv Ophthalmol. 2010 Jul-Aug;55(4):359-77.
17. Lim JI. Ophthalmic manifestations of sickle cell disease: update of the latest findings. Curr Opin Ophthalmol. 2012 Nov;23(6):533-6.
18. Judge DP, Dietz HC. Marfan’s syndrome. Lancet. 2005 Dec 3;366(9501):1965-76.
19. Nemet AY, Assia EI, Apple DJ, Barequet IS. Current concepts of ocular manifestations in Marfan syndrome. Surv Ophthalmol. 2006 Nov-Dec;51(6):561-75
20. Woodward LM. Ocular manifestations of phakomatoses. Int Ophthalmol Clin. 2014 Summer;54(3):105-10
21. Lubs ML, Bauer MS, Formas ME, Djokic B. Lisch nodules in neurofibromatosis type 1. N Engl J Med. 1991 May 2;324(18):1264-6.
22. Kinori M, Hodgson N, Zeid JL. Ophthalmic manifestations in neurofibromatosis type 1. Surv Ophthalmol. 2018 JulAug;63(4):518-533.
23. Cunningham ET Jr, Margolis TP. Ocular manifestations of HIV infection. N Engl J Med. 1998 Jul 23;339(4):236-44
24. Laovirojjanakul W, Thanathanee O. Opportunistic ocular infections in the setting of HIV. Curr Opin Ophthalmol. 2018 Nov;29(6):558-565.
25. Shields CL, Shields JA, Gross NE, Schwartz GP, Lally SE. Survey of 520 eyes with uveal metastases. Ophthalmology. 1997 Aug;104(8):1265-76.
26. Mathis T, Jardel P, Loria O, Delaunay B, Nguyen AM, Lanza F, Mosci C, Caujolle JP, Kodjikian L, Thariat J. New concepts in the diagnosis and management of choroidal metastases. Prog Retin Eye Res. 2019 Jan;68:144-176.
27. Konstantinidis L, Damato B. Intraocular Metastases--A Review. Asia Pac J Ophthalmol (Phila). 2017 Mar-Apr;6(2):208-214.
28. Zoltan A. Nagy, A History of Modern Immunology, 2014
29. C.S. Foster, Ocular autoimmune disease, an introduction. The ocular immunology and Uveitis foundation; Patel SJ, Lundy DC. Ocular manifestations of autoimmune disease. Am Fam Physician. 2002 Sep 15;66(6):991-8. PMID: 12358224.
30. Young S. Ocular involvement in connective tissue disorders. Curr Allergy Asthma Rep. 2005 Jul;5(4):323-6. doi: 10.1007/s11882005-0076-y. PMID: 15967077; Fernandez AP. Connective Tissue Disease: Current Concepts. Dermatol Clin. 2019 Jan;37(1):37-48. doi: 10.1016/j.det.2018.07.006. Epub 2018 Nov 1. PMID: 30466687
31. Abdulqader Y, Al-Ani M, Parperis K. Rheumatoid vasculitis: early presentation of rheumatoid arthritis. BMJ Case Rep. 2016 Nov 8;2016:bcr2016217557. doi: 10.1136/bcr-2016-217557. PMID: 27873751; PMCID: PMC5129099.
32. Evren Kemer O. Dry Eye in Rheumatoid Arthritis. Int Ophthalmol Clin. 2017 Spring;57(2):89-99. doi: 10.1097/ IIO.0000000000000166. PMID: 28282316;
33. Murray PI, Rauz S. The eye and inflammatory rheumatic diseases: The eye and rheumatoid arthritis, ankylosing spondylitis, psoriatic arthritis. Best Pract Res Clin Rheumatol. 2016 Oct;30(5):802-825. doi: 10.1016/j.berh.2016.10.007. Epub 2016 Nov 9. PMID: 27964790;
34. Abdulqader Y, Al-Ani M, Parperis K. Rheumatoid vasculitis: early presentation of rheumatoid arthritis. BMJ Case Rep. 2016 Nov 8;2016:bcr2016217557. doi: 10.1136/bcr-2016-217557. PMID: 27873751; PMCID: PMC5129099.
35 J Sieper, J Braun, M Rudwaleit, A Boonen, A Zink, Ankylosing spondylitis: an overview. Ann Rheum Dis 2002;61(Suppl III):iii8–iii18.
36. Ana Beatriz Santos Bacchiega Gustavo Guimara˜ es Moreira Balbi1, Manuella Lima Gomes Ochtrop, Francisco Assis de Andrade, Roger Abramino Levy, and Xenofon Baraliakos Ocular involvement in patients with spondyloarthritis Rheumatology 2017;56:2060-206
37. Alejandro Rodriguez MD, Yonca A. Akova MD, Miguel Pedroza-Seres MD, C. Stephen Foster Posterior Segment Ocular Manifestations in Patients with HLA-B27—associated Uveitis Ophthalmology Volume 101, Issue 7, July 1994, Pages 1267-1274]
38. Arvind Kaul, Caroline Gordon, Mary K. Crow, Zahi Touma, Murray B. Urowitz, Ronald van Vollenhoven, Guillermo Ruiz-Irastorza & Graham Hughes Systemic lupus erythematosus Nature Reviews Disease Primers volume 2, Article number: 16039 (2016); Farah Tamirou,1 Laurent Arnaud et al Systemic lupus erythematosus: state of the art on clinical practice guidelines Tamirou F, et al. RMD Open 2019;4:e000793.
39. Silpa-archa S, Lee JJ, Foster CS. Ocular manifestations in systemic lupus erythematosus. British Journal of Ophthalmology 2016;100:135-141;
40. Palejwala NV, Walia HS, Yeh S. Ocular manifestations of systemic lupus erythematosus: a review of the literature. Autoimmune Dis. 2012;2012:290898. doi:10.1155/2012/290898
41. De Virgilio A, Greco A, Magliulo G, Gallo A, Ruoppolo G, Conte M, Martellucci S, de Vincentiis M. Polyarteritis nodosa: A contemporary overview. Autoimmun Rev. 2016 Jun;15(6):564-70. doi: 10.1016/j.autrev.2016.02.015. Epub 2016 Feb 13. PMID: 26884100;
42. Akova YA, Jabbur NS, Foster CS. Ocular presentation of polyarteritis nodosa. Clinical course and management with steroid and cytotoxic therapy. Ophthalmology. 1993 Dec;100(12):1775-81. doi: 10.1016/s0161-6420(93)31405-3. PMID: 7903120;
43. Foster CS. Ocular manifestations of the potentially lethal rheumatologic and vasculitic disorders. J Fr Ophtalmol. 2013 Jun;36(6):526-32. doi: 10.1016/j.jfo.2012.12.004. Epub 2013 May 18. PMID: 23688612.
44. Ungprasert P, Ryu JH, Matteson EL. Clinical Manifestations, Diagnosis, and Treatment of Sarcoidosis. Mayo Clin Proc Innov Qual Outcomes. 2019;3(3):358-375. Published 2019 Aug 2. doi:10.1016/j.mayocpiqo.2019.04.006
45. Pasadhika S, Rosenbaum JT. Ocular Sarcoidosis. Clin Chest Med. 2015;36(4):669-683. doi:10.1016/j.ccm.2015.08.009 ;
46. Hayreh SS, Podhajsky PA, Zimmerman B. Ocular manifestations of giant cell arteritis. Am J Ophthalmol. 1998 Apr;125(4):50920. doi: 10.1016/s0002-9394(99)80192-5. PMID: 9559737;
47. Lee AG. Ocular manifestations of giant cell arteritis. Am J Ophthalmol. 1998 Nov;126(5):742-4. PMID: 9822250.
48. Saraci G, Treta A. Ocular changes and approaches of ophthalmopathy in basedow - graves- parry- flajani disease. Maedica (Bucur). 2011;6(2):146-152;
49. Bistriceanu M, Cergă A, Lichiardopol-Răducanu C. Graves’ ophthalmopathy. Oftalmologia. 1993 Mar-May;37(2):99-103. PMID: 8507632,
50. Stiebel-Kalish H, Robenshtok E, Gaton DD. Pathophysiology of Graves’ ophthalmopathy. Pediatr Endocrinol Rev. 2010 Mar;7 Suppl 2:178-81. PMID: 20467359
51. Barton JJ, Fouladvand M. Ocular aspects of myasthenia gravis. Semin Neurol. 2000;20(1):7-20. doi: 10.1055/s-2000-6829. PMID: 10874773.
52. Oh J, Vidal-Jordana A, Montalban X. Multiple sclerosis: clinical aspects. Curr Opin Neurol. 2018 Dec;31(6):752-759. doi: 10.1097/ WCO.0000000000000622. PMID: 30300239
53. Kale N. Optic neuritis as an early sign of multiple sclerosis. Eye Brain. 2016;8:195-202. Published 2016 Oct 26. doi:10.2147/ EB.S54131.
54. Ding J, Wong TY. Current epidemiology of diabetic retinopathy and diabetic macular edema. Curr Diab Rep. 2012 Aug;12(4):34654. doi: 10.1007/s11892-012-0283-6. PMID: 22585044;
55. Cheung N, Mitchell P, Wong TY. Diabetic retinopathy. Lancet. 2010 Jul 10;376(9735):124-36. doi: 10.1016/S0140-6736(09)62124-3. Epub 2010 Jun 26. PMID: 20580421
56. Textbook on clinical ocular pharmacology and therapeutics, SK Gupta et al. Jaypee Brothers Health Sciences Publishers 2014
Inherited retinal dystrophies
Anterior segment tumors
Posterior segment intraocular tumors
Francesco Testa, Francesca Simonelli
Retinitis pigmentosa
Retinitis pigmentosa (RP) comprises a heterogeneous group of inherited degenerative diseases of the retina that affect photoreceptors [1]
It is a rare disease, with a prevalence of about 1 in 4000 for a total of over 1 million affected individuals worldwide [2]. RP is due to mutations in approximately 100 currently known genes, and can be transmitted in an autosomal recessive, autosomal dominant, and X-linked recessive manner. However, nearly 50% of patients report no family history of the disease and are defined sporadic (isolated cases with no family history). Such cases can be determined by new dominant mutations, cases of uniparental isodisomy or, for males, by mutations of genes residing on the X chromosome. Non-Mendelian inheritance patterns, such as digenic inheritance and maternal (mitochondrial) inheritance, have been reported but are present in only a small percentage of patients [3] .
The anamnestic evaluation must aim at documenting the symptoms with particular attention to their onset, examining family history, and identifying eventual consanguinity in the parentage. The family tree is also important to defining genetic transmission. Finally, it is necessary to exclude iatrogenic causes, i.e. from phenothiazines, chloroquine, and quinine. In addition to drug toxicity, other causes of pigmentary retinopathy may be autoimmune retinopathy, syphilis, rubella, and more rarely toxoplasma or herpes virus infections [4] RP most frequently occurs in adolescence, although forms with an onset in early life and later forms in adulthood have been described. The typical initial symptom of the disease is delayed dark adaptation, which can progress to night blindness.
Subsequently, narrowing of the peripheral visual field may occur, and in more advanced forms there may be a progressive reduction of visual acuity, dyschromatopsia, and photophobia, often due to posterior subcapsular cataract.
Typical ocular signs of RP are represented by the following fundus changes: retinal pigment epithelium (RPE) dystrophy with bone spicules pigment deposits in the middle retinal periphery, decreased caliber of retinal vessels, and optic nerve pallor (Figure 1).
In some cases, in early stages of disease, the fundus appears normal; in others, retinal alterations are limited to a specific region, clinically configuring different atypical forms of the disease such as pericentral RP (Figure 2), sector RP (Figure 3), preserved periarteriolar RP, and sine pigmento RP.
Although most RP cases are non-syndromic, 20%-30% of RP patients have associated systemic diseases. The genetic syndromes associated with Retinitis pigmentosa are about 30; among which Usher Syndrome (Retinitis pigmentosa and bilateral sensorineural hearing loss), Bardet-Biedl Syndrome (Retinitis pigmentosa associated with mental retardation, hypogonadism, obesity and polydactyly), Kearns-Sayre Syndrome (mitochondrial myopathy manifesting Retinitis pigmentosa and ophthalmoplegia), and Refsum disease (caused by


retinal vessels, and optic nerve
near mid-periphery while the far periphery, within and beyond the vascular arcades, is overall preserved
a deficiency in phytanic acid metabolism, which causes its accumulation throughout the body; the affected subject has Retinitis pigmentosa, electrocardiographic alterations, deafness and ichthyosis) [5]
RP diagnosis can be hypothesized according to ocular signs and symptoms and confirmed by kinetic perimetry and electroretinogram (ERG). Kinetic perimetry shows concentric reductions of the peripheral isopters with progressive narrowing until only a small central island of vision remains, the so-called tubular visual field. ERG tracings show a progressive reduction of scotopic a and b wave amplitudes (rods) that can also be associated with a reduction in photopic responses (cones). In the final stages of the disease, ERG may result non-recordable [6] OCT is particularly useful in RP patients to evaluate macular structure and identify complications, such as cystoid macular edema (Figure 4) and epiretinal membrane, common in RP [7] There is no therapy for Retinitis pigmentosa, except for the form due to mutations in the RPE65 gene, which is currently treatable with the drug Luxturna (see the Leber congenital amaurosis section) [8, 9]. In addition, numerous gene therapy trials are underway to treat disease forms associated with other genes, such as MERTK and RPGR [10] . Visual rehabilitation provides support and training, including orientation and mobility training combined with low vision aids such as night vision goggles and/or reverse telescopes to optimize residual visual function.
Furthermore, nutritional support therapies have been shown to be useful in slowing disease progression. Vitamin A palmitate (15,000 international units [IU] per day) slows the progression of the disease by about 2% per year and docosahexaenoic acid (DHA) (at least 1.4 g per week) slows visual field loss by 40%-50% compared to patients who consume fewer omega-3 fatty acids [11-13] .
Some RP related complications, such as cataracts and cystoid macular edema, are open to treatment. For the treatment of cystoid macular edema, oral carbonic anhydrase inhibitors, such as acetazolamide or topical dorzolamide, are used.

Subcapsular cataract, present in about 1/3 of RP patients, can be treated with lens phacoemulsification and intraocular lens implantation.
Usher Syndrome (USH) comprises a group of clinically variable and genetically heterogeneous autosomal recessive disorders characterized by the association of sensorineural hearing loss, Retinitis Pigmentosa (RP), and, in some cases, vestibular dysfunction [14] It is the most frequent cause of deaf-blindness and prevalence has been estimated between 1.8 and 6.2 cases per 100,000 [15]
The eye disease in USH patients consists of a progressive retinal photoreceptor degeneration with consequent loss of peripheral vision and reduction of visual acuity later in the course of disease. This condition is predominantly attributable to rod dysfunction, although cones also degenerate later. Ocular findings may vary and include night blindness, abnormal ERG responses, visual field constriction, abnormal retinal pigmentation including peripheral bone spicules, arterial narrowing, and optic-nerve pallor [16] .
While hearing loss in USH can be counteracted by cochlear implantation, RP remains untreatable [14]. RP provides a definitive clinical diagnosis of USH and distinguishes it from non-syndromic sensorineural hearing impairment.
RP in USH is clinically similar to non-syndromic RP where visual loss begins with deterioration of peripheral and night vision. Central vision is ultimately lost, often in later adulthood. Anterior-segment exam is important to rule out posterior subcapsular cataracts, which develop in up to 50% of patients. The diagnosis is made by retinal biomicroscopy, visual field evaluation, and ERG. Fundus findings include arteriolar narrowing, mild pallor of the disc, and bone spicule-like pigment changes in the midperiphery, although atypical phenotypes such as pericentral RP have also been reported. Goldmann Visual fields typically show scotomas in the mid-periphery that enlarge over years, with central vision preserved until late. ERG usually shows a markedly reduced or extinguished response. In early stages of the disease, rod ERG amplitude is affected more than that of cones. In advanced stages, both rod and cone responses are extinguished [16]
In addition to a standard clinical evaluation, OCT and fundus autofluorescence are useful. OCT detects and monitors foveal lesions such as epiretinal membrane or cystoid macular edema, potentially reversible causes of vision loss in RP [17]
Fundus autofluorescence quantifies RPE atrophy if it is clinically uncertain. USH can be divided into three clinical subgroups according to their audiovestibular features, onset of disease, progression, and severity of symptoms [18]
USH1 is the most severe form. USH1 patients suffer from severe to profound prelingual congenital and bilateral sensorineural hearing loss. Children do not benefit from hearing aids and can develop normal speech only when they receive cochlear implants. USH1 children also have vestibular areflexia and absent vestibular function. The vestibular problems are nearly always manifested by a motor delay. They are slow to gain head control and sit unsupported and rarely walk before 18 months. Profound hearing loss leading to delayed language development combined with motor delay can be misinterpreted as global delay, hence careful clinical observation and questioning is mandatory. RP is not manifest during infancy, although anomalies of light-evoked electrical response of the retina can be detected only by ERG at 2-3 years of age [18] [19] [20]
USH2 is clinically distinct from USH1. Hearing loss is also congenital but post-lingual with the higher frequencies being more severely affected. These patients can gain benefit from conventional hearing aids and learn to speak normally. The vestibular function is normal, and the degree of hearing loss is moderate, not progressive, and patients are initially diagnosed as having non-syndromic hearing loss. Usher diagnosis is often not made until the symptoms of RP (at or around puberty usually), night blindness and constricted visual fields, become apparent or the patient undergoes routine ophthalmic examination [21] [19] USH3 is a less common form, except in such populations as Finns and Ashkenazi Jews. In USH3 there is mild to severe progressive post-lingual hearing loss. A significant progression of hearing loss is apparent in the first two decades of life with a period of stabilization and then future progression between the fourth and fifth decades, with onset of RP in the teenage years. USH3 resembles USH2 except for progressive worsening of hearing [19]
To date, fourteen loci have been associated with USH: nine are involved in USH1, three in USH2, one in USH3, and one not specified. From these loci, eleven genes have been identified. They include six USH1, three USH2, one USH3, and one USH having a potential role as a disease modifier (PDZD7).
For USH1, the most mutated gene is MYO7A, which accounts for about 50% of cases in most populations studied; CDH23 and PCDH15 are frequently the next most mutated genes. About 80% of USH2 cases are caused by USH2A, with around 10% or less caused by GPR98. Molecularly proven cases of USH3 appear to be rare in most populations [22]. With the advent of Next Generation Sequencing (NGS), multiple genes can be screened quickly and in parallel, reducing costs. This allows earlier diagnosis in children [23]. It also allows the pre-symptomatic diagnosis of USH2 and USH3, which may be beneficial in terms of preventive or restorative visual therapies that are being developed and trialed.
Today there is no standardized treatment of vision loss in USH; however, in recent years there have been enormous efforts toward the development of various therapeutic strategies.
Gene augmentation therapy is currently the most advanced therapeutic strategy for inherited retinal degenerations. In this approach, wild-type cDNA of the mutated gene is delivered to the retina. Viral vectors, mostly adeno-associated viruses (AAV) or lentiviruses are used for gene delivery. Phase I/II studies with USH1B patients using AAV for the delivery of MYO7A are underway following a longitudinal prospective natural history study (NCT03814499) [14]
Cone dystrophies and cone-rod dystrophies are an extremely heterogeneous group of IRDs, both clinically and genetically [24]
Cone dystrophy is a degenerative retinal disease with specific involvement of cones and progressive worsening of visual acuity. Disease onset generally occurs in adolescence, or less frequently in the second to third decade of life. The main symptoms are represented by a progressive reduction of central visual acuity, photophobia, and, often, nystagmus. Unlike other macular diseases, color vision impairment occurs early in the course of the disease. Typically, all three types of cones are affected with a color vision disorder that involves all three chromatic axes [25] .
Fundus examination is not always indicative; hence, clinical history and electro-functional tests are necessary. Visual field, fluorescein angiogram, OCT, and microperimetry testing can provide additional information to define the diagnosis.
Symptoms usually precede fundus changes that are minimal or almost completely absent in the early stages of the disease; these alterations may consist of a “bull’s eye” maculopathy, RPE dystrophy in the macular region (Figure 5), or, less frequently, macular atrophy, which is usually associated with a temporal pallor of the optic disc of varying degrees.
Visual field reveals a central scotoma, while peripheral visual field is preserved. Microperimetry can be useful for monitoring macular sensitivity in the follow-up of the disease.
OCT often shows alterations in foveal thickness with or without RPE dystrophy.
Cone dystrophy presents with severely reduced or non-recordable photopic ERG tracings, while the scotopic component is normal; this ERG finding is the essential element for diagnosis; in fact, fluorescein angiogram and fundus appearance can present normal even when the photopic ERG tracing is extinct.
As the disease progresses, a substantial number of patients initially diagnosed with cone dystrophy may experience rod-cone dystrophy with the onset of night blindness and ERG changes in the scotopic system. In these conditions, RP-like fundus lesions can also develop [26].
Cone-rod dystrophies are hereditary retinal dystrophies belonging to the group of pigmented


retinopathies. The estimate is about 1 in 40,000 cases. These forms are often isolated but can also be present in syndromes such as spinocerebellar ataxia type 7, amelogenesis imperfecta, neurofibromatosis type 1, Bardet-Biedl syndrome, Alstrom syndrome, and ataxia of Pierre Marie. Cones are usually affected before rods but at times there is a concomitant loss of both photoreceptor elements with greater involvement of cones [27]
These alterations cause reduced central visual acuity, alteration of color vision, photophobia, and reduced sensitivity of central visual field, which in the course of the disease are accompanied by a progressive loss of peripheral visual field and night blindness.
The main onset symptom is the reduction of central visual acuity, which usually occurs in school age. Then intense photophobia and a variable degree of dyschromatopsia occur. Night blindness, altered peripheral visual field, reduced visual acuity (to 20/200 or less), and nystagmus appear later with the advancing of the disease.
Reduced visual acuity, photophobia, fundus lesions, abnormal ERG response, with noticeable cone involvement, lead to Cone-rod diagnosis. ERG is the essential test for diagnosis, especially in the early stages of the disease when the fundus appears normal. Considering that in early phases only cones are involved, it is important to repeat ERG testing a few years after the first assessment for a correct diagnostic classification.
The fundus may initially appear within the normal limits; subsequently pigment deposits occur in the posterior pole and various degrees of retinal atrophy in the macular region. The retinal vessels may be of normal or moderately reduced caliber. The temporal portion of the optic disc, consisting of the bundle of nerve fibers coming from the macular region, is often slightly pale.
Electroretinographically, the disease presents with an increased latency of photopic a and b waves. With disease progression there is a reduced amplitude of the photopic trace, which may precede or accompany a milder reduction of the scotopic trace.
Visual field examination initially shows a central scotoma with sparing of the periphery, while in more advanced stages narrowing of the peripheral isopters is also observed.
Multifocal ERG may be useful for an accurate monitoring of macular function in the follow-up
of the disease.
Clinical heterogeneity of cone and cone-rod dystrophies is directly related to genetic heterogeneity. All three dominant, recessive, and X - linked Mendelian inheritance patterns are associated with the disease.
Mutations in more than 30 genes have been shown to cause cone or cone-rod dystrophy. The encoded proteins are involved in a variety of processes including the cone phototransduction cascade (e.g., GUCY2D), the visual cycle (e.g., ABCA4), photoreceptor development (e.g., CRX), and the ciliary structure and transport (e.g., RPGR).
Most individuals with cone or cone-rod dystrophy have autosomal recessive forms. Autosomal dominant inheritance is less common, and only a few cases have the X-linked subtype. A significant part of the cases (> 30%) remain unresolved. Commonly mutated genes include ABCA4 (autosomal recessive), GUCY2D (autosomal dominant), PRPH2 (autosomal dominant), CRX (autosomal dominant), KCNV2 (autosomal recessive), and RPGR (X-linked) [28]
There are currently no therapies available for progressive cone dystrophies and cone-rod dystrophies [29]. However, different strategies can be adopted that can slow down the course of the disease: protection from light with medical filters, a balanced diet, refraining from smoking, taking supplements. Much attention must be paid to the use of vitamin A, which in the case of patients whose disease is caused by mutations in the ABCA4 gene, such as in Stargardt disease, must be limited as it is hypothesized that it can support the degenerative process. It is important to treat some complications, such as cataracts and cystoid macular edema, which are often the cause of loss in central visual acuity.
Leber congenital amaurosis (LCA) is an inherited retinal dystrophy that causes blindness or severe visual impairment at birth or within the first six months of life. It represents one of the most frequent causes of congenital blindness, with an incidence worldwide of about 3 cases out of every 100,000 newborns and represents about 5% of all inherited retinal dystrophies [30]
Transmission is generally autosomal recessive, although cases with autosomal dominant inheritance have also been reported. To date, mutations causing LCA have been identified in 15 different genes, but the number of genes associated with the disease is believed to be greater, considering that the genetic cause in a significant percentage of patients has not yet been identified. Although these genes encode proteins with different functions in the retina and retinal pigment epithelium, the associated phenotypes are often similar. A classification has been made according to genotype: for example, LCA type I due to mutations in the GUCY2D gene, LCA type II due to mutations in the RPE65 gene [31]
A careful anamnestic evaluation must pay particular attention to the onset of symptoms, family history, and identification of possible consanguinity in the parentage. Defining genetic transmission through the description of the family tree also supports diagnosis. Symptoms most frequently associated with the disease are early and severe reduction in central visual acuity, night blindness, photophobia, or light gazing. The disease manifests very early, around six months of life, with changes in ocular motility such as nystagmus or roving eye movements, lack of fixation, and sluggish pupillary reflexes. Franceschetti’s oculo-digital sign is a sign frequently associated with LCA and consists in the repeated pressure exerted by the subject on the eyes and orbits with fingers or the back of the hands and in the frequent rubbing of the eyes. Fundus appearance is extremely variable. It may be normal, especially in early stages of disease, or more frequently, presenting salt and pepper dystrophy (Figure 6) up to diffuse RPE dystrophy with osteoblast-like pigment accumulation, as can be observed in RP. The disease


can also be associated with hyperopia and keratoconus and more rarely ptosis, strabismus, microphthalmos, macular coloboma, or edema of the optic disc.
The diagnosis can be hypothesized based on signs and symptoms of severe visual impairment, early onset, familiarity or consanguinity of parents, and abnormal ophthalmoscopic fundus findings; however, the essential test for diagnosis is ERG, which results in non-recordable or markedly hypovolted scotopic and photopic responses [32]
Although LCA principally involves eyes, some syndromic forms are also known, such as Senior-Loken syndrome with renal involvement (nephronophthisis); Saldino-Mainzer syndrome, characterized by skeletal anomalies (which include osteopetrosis, cone-shaped epiphysis) and ataxia; and Joubert Syndrome, characterized by cerebellar hypoplasia, oculomotor abnormalities, and breathing problems.
Currently, there is no treatment for LCA, and patient support consists of disease management, with rehabilitation programs for low vision and blindness. One exception is the gene therapy treatment with the drug voretigene neparvovec (Luxturna) for LCA type II, due to mutations in the RPE65 gene. The drug, an adenoviral vector containing the corrected copy of the RPE65 gene, is administered via a single subretinal injection, and is indicated in patients with biallelic mutations of the RPE65 gene with a sufficient number of viable retinal cells. This therapeutic solution represents a significant turning point in the management of incurable IRDs, allowing us to hypothesize that therapies for other forms of the disease may be available in the next years [8, 33, 34]
Stargardt juvenile macular dystrophy is an inherited maculopathy. Stargardt disease is classically transmitted with an autosomal recessive trait and is associated with mutations in the ABCA4 gene (STGD1), located on chromosome 1 in position p21-p13. The ABCA4 protein plays a fundamental role in the retinal metabolism of vitamin A, which is why its dysfunction causes an accumulation of one of its metabolites at the RPE level, in particular, N-retinylidene-N-retinyl-ethanolamine (A2E), the main component of lipofuscin [35]

Some forms of autosomal dominant inherited disease associated with mutations in the ELOVL4 (STGD3) and PROM1 (STGD4) genes have been described [36] Stargardt disease is the most frequent macular dystrophy, with a prevalence between 1/8000 and 1/10000. It is estimated that it accounts for approximately 7% of all IRDs [37] The anamnestic evaluation must aim at documenting the symptom onset, family history, and eventual consanguinity in the parentage. Furthermore, defining genetic transmission through the description of the family tree supports the diagnosis. The main symptom of the disease is a rapid loss of central visual acuity, which can be reduced from 20/20 to 20/200, and more rarely to finger counts or hand movement. The onset of the disease classically occurs in the first two decades of life, although about 20% of patients do not report a loss in visual acuity until the fourth decade of life [38] .
In the initial stages, a loss of the foveal reflex with a granular appearance of the macular RPE may be observed, subsequently an atrophic maculopathy appears. In many patients, characteristic yellowish, slightly elongated lesions called “flecks” are observed. When the “flecks” are widespread in the macular region, the fundus is described with the term fundus flavimaculatus.
Based on the ophthalmoscopic aspects, three stages of Stargardt disease are recognized: Stage 1: initial RPE alterations in the macular region (Figure 7), which can vary from slight alterations up to an atrophy and gives the macula a “beaten bronze” appearance. Stage 2: presence of “flecks” around the macular region or extending up to the vascular arches (Figure 8). Stage 3: extensive RPE atrophy involving the entire posterior pole (Figure 9) [39]
Stargardt diagnosis can be hypothesized by analyzing ocular symptoms and signs and is supported by the following diagnostic investigations: OCT, FAF, ERG. OCT is today an examination of considerable clinical relevance in Stargardt disease, because macular changes are visible even in initial stages when ophthalmoscopic changes are absent or minimal. The most evident OCT finding is the reduction of foveal thickness in conjunction with progressive macular atrophy (Figure 10) [40] .
Autofluorescence fundus examination using a laser scanning system (cSLO) allows a detailed
Figure 10. Optical coherence tomography scan in a patient with Stargardt disease showing a reduced foveal thickness due to the absence of photoreceptorial layer and retinal pigment epithelium dystrophy
assessment of the extent of macular atrophy, which appears as the absence of an autofluorescence signal, and of “flecks,” which appear as loci with a high autofluorescence signal (Figure 11). Macular atrophy, typical in more advanced forms of disease, is sometimes difficult to observe ophthalmoscopically, therefore, fundus examination in FAF helps in assessing atrophy progression [41]. Finally, patients with Stargardt disease show different degrees of functional alteration, as evidenced by ERG. Pattern ERG is markedly reduced or extinct already in early stages of disease. Standard ERG may present with normal or subnormal scotopic and photopic responses. Three classes of functional alterations are distinguished: Class I: normal response of both scotopic and photopic components; Class II: normal scotopic response and altered photopic response; Class III: altered response of both scotopic and photopic components [42] .
Fluorescein angiogram, in most cases, shows a loss of hyperfluorescence from the choroid, a condition defined as a sign of “choroidal silence.” However, this sign is not pathognomonic

Figure 11. Autofluorescence fundus imaging of patient with Stargardt disease, showing a fundus flavimaculatus, which appears as the absence of an autofluorescence signal in macula and loci with a high autofluorescence signal throughout the posterior pole, the so-called “flecks”
of Stargardt disease; therefore, considering the invasiveness of the technique and the limited information it provides, it is not currently an indispensable examination [43] Currently there is no treatment for Stargardt disease, although various experimental drug and gene therapy strategies are being studied. The drug therapies that are considered most promising now are based on the use of isoprenoid antagonists of RPE65 and lutein. RPE65 antagonist isoprenoids block the regeneration of 11-cis-retinal (vitamin A), inhibiting the visual cycle preventing the formation of retinotoxic lipofuscins. Therefore, the dietary intake of vitamin A should be reduced in patients with ABCA4 gene mutations. Macular pigments (lutein and zeaxanthin) contribute to macular protection from light. Exposure to light not only causes lipofuscin accumulation but increases its potential toxicity through photo-oxidation. Lutein supplementation in patients with ABCA4 mutations has been shown to have protective effects on visual function. Finally, gene therapy strategies are based on the release of the healthy ABCA4 gene, through the subretinal injection of vectors consisting of lentiviruses or adeno-associated viruses. The efficient transduction of photoreceptors and the significant reduction of lipofuscin accumulation, in animal models without the gene (ABCA4 - / -), demonstrate that gene therapy can become an effective treatment for Stargardt disease [38]
References
1. Hamel C. Retinitis pigmentosa. Orphanet J Rare Dis. 2006;1:40.
2. Fahim AT, Daiger SP, Weleber RG. Nonsyndromic retinitis pigmentosa overview. GeneReviews®[Internet]: University of Washington, Seattle; 2017.
3. Rivolta C, Berson EL, Dryja TP. Mutation screening of the peropsin gene, a retinal pigment epithelium specific rhodopsin homolog, in patients with retinitis pigmentosa and allied diseases. Mol Vis. 2006;12:1511-5.
4. Hartong DT, Berson EL, Dryja TP. Retinitis pigmentosa. Lancet. 2006;368(9549):1795-809.
5. Mrejen S, Audo I, Bonnel S, Sahel JA. Retinitis Pigmentosa and Other Dystrophies. Dev Ophthalmol. 2017;58:191-201.
6. Zobor D, Zrenner E. [Retinitis pigmentosa - a review. Pathogenesis, guidelines for diagnostics and perspectives]. Ophthalmologe. 2012;109(5):501-14;quiz 15.
7. Testa F, Melillo P, Di Iorio V, Orrico A, Attanasio M, Rossi S, et al. Macular function and morphologic features in juvenile stargardt disease: longitudinal study. Ophthalmology. 2014;121(12):2399-405.
8. Testa F, Melillo P, Della Corte M, Di Iorio V, Brunetti-Pierri R, Citro A, et al. Voretigene Neparvovec Gene Therapy in Clinical Practice: Treatment of the First Two Italian Pediatric Patients. Transl Vis Sci Technol. 2021;10(10):11.
9. Testa F, Murro V, Signorini S, Colombo L, Iarossi G, Parmeggiani F, et al. RPE65-Associated Retinopathies in the Italian Population: A Longitudinal Natural History Study. Invest Ophthalmol Vis Sci. 2022;63(2):13.
10. Verbakel SK, van Huet RAC, Boon CJF, den Hollander AI, Collin RWJ, Klaver CCW, et al. Non-syndromic retinitis pigmentosa. Prog Retin Eye Res. 2018;66:157-86.
11. Berson EL, Rosner B, Sandberg MA, Hayes KC, Nicholson BW, Weigel-DiFranco C, et al. A randomized trial of vitamin A and vitamin E supplementation for retinitis pigmentosa. Arch Ophthalmol. 1993;111(6):761-72.
12. Berson EL, Rosner B, Sandberg MA, Weigel-DiFranco C, Willett WC. omega-3 intake and visual acuity in patients with retinitis pigmentosa receiving vitamin A. Arch Ophthalmol. 2012;130(6):707-11.
13. Berson EL, Weigel-DiFranco C, Rosner B, Gaudio AR, Sandberg MA. Association of Vitamin A Supplementation With Disease Course in Children With Retinitis Pigmentosa. JAMA Ophthalmology. 2018;136(5):490-5.
14. Toms M, Pagarkar W, Moosajee M. Usher syndrome: clinical features, molecular genetics and advancing therapeutics. Ther Adv Ophthalmol. 2020;12:2515841420952194.
15. Boughman JA, Vernon M, Shaver KA. Usher syndrome: definition and estimate of prevalence from two high-risk populations. J Chronic Dis. 1983;36(8):595-603.
16. Fleischhauer J, Njoh WA, Niemeyer G. Syndromic retinitis pigmentosa: ERG and phenotypic changes. Klin Monbl Augenheilkd. 2005;222(3):186-90.
17. Testa F, Melillo P, Rossi S, Marcelli V, de Benedictis A, Colucci R, et al. Prevalence of macular abnormalities assessed by optical coherence tomography in patients with Usher syndrome. Ophthalmic Genet. 2018;39(1):17-21.
18. Delmaghani S, El-Amraoui A. The genetic and phenotypic landscapes of Usher syndrome: from disease mechanisms to a new classification. Hum Genet. 2022.
19. Stingl K, Kurtenbach A, Hahn G, Kernstock C, Hipp S, Zobor D, et al. Full-field electroretinography, visual acuity and visual fields in Usher syndrome: a multicentre European study. Doc Ophthalmol. 2019;139(2):151-60.
20. Testa F, Melillo P, Bonnet C, Marcelli V, de Benedictis A, Colucci R, et al. Clinical Presentation and Disease Course of Usher Syndrome Because of Mutations in Myo7a or Ush2a. Retina. 2017;37(8):1581-90.
21. Tsilou ET, Rubin BI, Caruso RC, Reed GF, Pikus A, Hejtmancik JF, et al. Usher syndrome clinical types I and II: could ocular symptoms and signs differentiate between the two types? Acta Ophthalmol Scand. 2002;80(2):196-201.
22. Millan JM, Aller E, Jaijo T, Blanco-Kelly F, Gimenez-Pardo A, Ayuso C. An update on the genetics of usher syndrome. J Ophthalmol. 2011;2011:417217.
23. Bonnet C, Riahi Z, Chantot-Bastaraud S, Smagghe L, Letexier M, Marcaillou C, et al. An innovative strategy for the molecular diagnosis of Usher syndrome identifies causal biallelic mutations in 93% of European patients. Eur J Hum Genet. 2016;24(12):1730-8.
24. Michaelides M, Hardcastle AJ, Hunt DM, Moore AT. Progressive cone and cone-rod dystrophies: phenotypes and underlying molecular genetic basis. Surv Ophthalmol. 2006;51(3):232-58.
25. Thiadens AA, Phan TM, Zekveld-Vroon RC, Leroy BP, van den Born LI, Hoyng CB, et al. Clinical course, genetic etiology, and visual outcome in cone and cone-rod dystrophy. Ophthalmology. 2012;119(4):819-26.
26. Roosing S, Thiadens AA, Hoyng CB, Klaver CC, den Hollander AI, Cremers FP. Causes and consequences of inherited cone disorders. Prog Retin Eye Res. 2014;42:1-26.
27. Hamel CP. Cone rod dystrophies. Orphanet J Rare Dis. 2007;2:7.
28. Tsang SH, Sharma T. Progressive Cone Dystrophy and Cone-Rod Dystrophy (XL, AD, and AR). Adv Exp Med Biol. 2018;1085:5360.
29. Gill JS, Georgiou M, Kalitzeos A, Moore AT, Michaelides M. Progressive cone and cone-rod dystrophies: clinical features, molecular genetics and prospects for therapy. Br J Ophthalmol. 2019.
30. Kumaran N, Moore AT, Weleber RG, Michaelides M. Leber congenital amaurosis/early-onset severe retinal dystrophy: clinical features, molecular genetics and therapeutic interventions. Br J Ophthalmol. 2017;101(9):1147-54.
31. den Hollander AI, Roepman R, Koenekoop RK, Cremers FP. Leber congenital amaurosis: genes, proteins and disease mechanisms. Prog Retin Eye Res. 2008;27(4):391-419.
32. Foxman SG. Diagnostic Criteria for Leber’s Congenital Amaurosis. Arch Ophthalmol. 1987;105(10):1319-20.
33. Simonelli F, Maguire AM, Testa F, Pierce EA, Mingozzi F, Bennicelli JL, et al. Gene therapy for Leber’s congenital amaurosis is safe and effective through 1.5 years after vector administration. Mol Ther. 2010;18(3):643-50.
34. Maguire AM, High KA, Auricchio A, Wright JF, Pierce EA, Testa F, et al. Age-dependent effects of RPE65 gene therapy for Leber’s congenital amaurosis: a phase 1 dose-escalation trial. Lancet. 2009;374(9701):1597-605.
35. Allikmets R. Simple and complex ABCR: genetic predisposition to retinal disease. Am J Hum Genet. 2000;67(4):793-9.
36. Sheremet NL, Zhorzholadze NV, Ronzina IA, Grushke IG, Kurbatov SA, Chukhrova AL, et al. [Molecular genetic diagnosis of Stargardt disease]. Vestn Oftalmol. 2017;133(4):4-11.
37. Tee JJ, Smith AJ, Hardcastle AJ, Michaelides M. RPGR-associated retinopathy: clinical features, molecular genetics, animal models and therapeutic options. Br J Ophthalmol. 2016;100(8):1022-7.
38. Cremers FPM, Lee W, Collin RWJ, Allikmets R. Clinical spectrum, genetic complexity and therapeutic approaches for retinal disease caused by ABCA4 mutations. Prog Retin Eye Res. 2020;79:100861.
39. Fishman GA, Farber M, Patel BS, Derlacki DJ. Visual acuity loss in patients with Stargardt’s macular dystrophy. Ophthalmology. 1987;94(7):809-14.
40. Testa F, Rossi S, Sodi A, Passerini I, Di Iorio V, Della Corte M, et al. Correlation between photoreceptor layer integrity and visual function in patients with Stargardt disease: implications for gene therapy. Invest Ophthalmol Vis Sci. 2012;53(8):440915.
41. Melillo P, Testa F, Rossi S, Di Iorio V, Orrico A, Auricchio A, et al. En Face Spectral-Domain Optical Coherence Tomography for the Monitoring of Lesion Area Progression in Stargardt Disease. Invest Ophthalmol Vis Sci. 2016;57(9):OCT247-52.
42. Lois N, Holder GE, Bunce C, Fitzke FW, Bird AC. Phenotypic subtypes of Stargardt macular dystrophy-fundus flavimaculatus. Arch Ophthalmol. 2001;119(3):359-69.
43. Bonnin MP. [The choroidal silence sign in central tapetoretinal degenerations examined by fluorescein]. Bull Soc Ophtalmol Fr. 1971;71(3):348-51.
Maria Antonietta Blasi, Federico Giannuzzi, Monica Maria Pagliara, Maria Grazia Sammarco
The squamous family comprises the most common neoplasms of the ocular surface. The most prevalent benign variant among these is squamous papilloma. Conjunctival papilloma is a benign tumor that develops from the outer layer of conjunctival cells. It can occur in individuals of all ages, including children and adults, usually exhibiting a gradual and progressive pattern. 2
Squamous papilloma can be classified into two subgroups based on clinical presentation: pedunculated and sessile. A pedunculated papilloma is a protruding pink-red growth resem-
Cysts of the conjunctiva and caruncle
- Conjunctival epithelial inclusion cyst
Reactive, epithelial, and degenerative conjunctival lesions
- Reactive epithelial hyperplasia
Tumor-like lesions and choristomas of the conjunctiva
- Papillary and follicular conjunctivitis
- Pterygium and pinguecula
Choristomas
- Epibulbar choristoma (dermoid; dermolipoma; complex)
- Epibulbar osseous choristoma
Benign epithelial tumors
- Conjunctival squamous papilloma
- Conjunctival oncocytoma
- Hereditary benign intraepithelial dyskeratosis
Epithelial tumors of the conjunctiva
Melanocytic conjunctival tumors
Lymphoid lesions
Table. Conjunctival tumors Classification1
Premalignant and malignant epithelial tumors of the conjunctiva
- Conjunctival squamous cell carcinoma
- Conjunctival squamous cell carcinoma
- Adenosquamous carcinoma
Benign conjunctival melanocytic tumor
- Benign epithelial melanosis of the conjunctiva
- Junctional, compound, and subepithelial naevi
- Inflamed juvenile conjunctival nevus
- Blue nevus of the conjunctiva
- WNT-activated DPN
- Combined conjunctival nevus
Premalignant and malignant melanocytic conjunctival tumors
- Conjunctival melanocytic intraepithelial lesions
- Conjunctival melanoma
Benign lymphoid hyperplasia
Non-Hodgkin lymphomas
bling a strawberry frond. It is commonly found in the caruncle, plica semilunaris, or forniceal conjunctiva, occurring more frequently in adolescents and young adults. Affected individuals may present with several lesions. Conjunctival papilloma is linked to human papillomavirus (HPV) 3 Currently, it is known to be caused by low-risk HPV types 6 and 11, as well as high-risk HPV types 16 and 33.3-5
Histological analysis reveals elongated extensions of overgrown squamous epithelium with a fibrovascular core at its center. Normal conjunctival epithelium may contain goblet cells. When the tear film is disrupted and exposed, the number of goblet cells may decrease, and the surface may become keratinized. 6
Within the epithelium, neutrophils can be observed, and the stroma often contains a persistent presence of chronic inflammatory cells in the stroma. Pedunculated papillomas often display benign characteristics and hardly undergo malignant conversion.7
A sessile papilloma typically develops on the bulbar conjunctiva, often near the limbus, and is more frequent in adults. This type of papilloma is also linked to HPV infection, specifically subtypes 16 and 18, which are the same subtypes implicated with squamous malignancies.8 Concerning signs for malignant transformation include leukoplakia (white patches indicating keratinization), inflammation, abnormal vascularity, and corneal involvement. Histologically, a sessile papilloma is characterized by a wide base and lacks the prominent finger-like extensions observed in a pedunculated papilloma. The epithelium exhibits hyperplasia with fibrovascular centers but is otherwise unremarkable. The observation of nuclear hyperchromatism and pleomorphism, along with dysplasia, dyskeratosis, and numerous mitotic figures, indicates a diagnosis of ocular surface squamous neoplasia. 7
Surgical excision is often necessary for the treatment of conjunctival papilloma. Additional treatments, such as perilesional cryotherapy, intralesional or topical interferon-α injection, carbon dioxide (CO2) laser, topical mitomycin-C (MMC), and oral cimetidine, have been documented as supplementary interventions.
The most prevalent malignant tumors among those affecting the conjunctiva include ocular surface squamous neoplasia (OSSN) (14%), melanoma (12%), and lymphoma (7%). Ocular surface squamous neoplasia refers to a condition characterized by the abnormal growth of squamous cells on the surface of the eye.
Ocular surface squamous neoplasia (OSSN) is a range of abnormal changes in the epithelium of the ocular surface.
This includes dysplastic changes in the conjunctiva and cornea, as well as the presence of intraepithelial neoplasia (carcinoma in situ) and invasive squamous cell carcinoma, which penetrates the epithelial basement membrane.
Ocular surface squamous neoplasia (OSSN) is more common in equatorial regions worldwide. The cause of OSSN is influenced by multiple factors.
The most commonly identified associations in several studies include ultraviolet B (UVB) light rays, human papillomavirus (HPV), specifically subtypes 16 and 189, human immunodeficiency (HIV) 1 and 2 viruses, and Hepatitis B and C. It is widely acknowledged that the incidence of OSSN is higher in populations residing within 30 degrees latitude of the equator. 10, 11 Various predisposing factors include chronic tobacco smoking, the use of n of petroleum products, hypopigmentation of hair and eyes, xerophthalmia ( vitamin A deficiency), exposure to chemicals, such as arsenic and beryllium, and ocular surface trauma.
OSSN often represents the initial manifestation of HIV/AIDS in areas with a high prevalence of HIV infection. HIV-associated ocular surface squamous neoplasia (OSSN) may exhibit accel-
erated proliferation and a highly aggressive nature. Therefore, the presence of HIV infection should be considered in individuals under 50 years of age presenting with OSSN. 10
The diagnosis is supported by the morphological features of the lesion, which can be distinguished in:
1. Papillomatous - Benign OSSN, ranging from pink to cherry red, exophytic, and strawberry-like. These lesions have a dotted red appearance, with the red areas due to the fibrovascular core of the lesion.
2. Leukoplakic - Pre-invasive lesions. These have surface hyperkeratinization associated with thickening and whitish appearance of the tumor.
3. Gelatinous - They are circumscribed and display the hairpin configuration of conjunctival vessels. They are further divided into nodular and diffuse types. The nodular type is localized, has well-defined margins, and spread to nearby lymph nodes. In contrast, the diffuse type is less common and involves the conjunctiva masquerading as chronic conjunctivitis. This type is slow-growing, with tumefaction occurring late in the disease process.
The diagnosis is also supported by some specific examinations: High resolution optical coherence tomography (HR-OCT), Ultrasound biomicroscopy (UBM) and In-vivo confocal microscopy (IVCM).
– High resolution optical coherence tomography (HR-OCT): HR-OCT images of OSSN display 3 distinct features: 1. thickened, 2. hyperreflective epithelium with a 3. rapid transition from normal to abnormal epithelium.12 HR-OCT can also be used intra-operatively to better visualize tumor margins and guide surgical excision of these lesions. In cases of more invasive squamous cell carcinoma (SCC), HR-OCT images can also reveal a subepithelial component.
– UBM can effectively pass through opaque ocular surface lesions, determine the presence of invasion, and provide a view of the tumor’s posterior margin. However, this comes at the cost of reduced axial resolution, ranging from 20 to 50 μm. Unlike HR-OCT, UBM necessitates direct ocular contact. Furthermore, image acquisition and interpretation necessitate the expertise of a proficient technician or provider.13 UBM has demonstrated its efficacy in evaluating the extent of penetration and invasion in various ocular surface tumors. However, its usefulness is restricted when evaluating noninvasive conditions.14
In-vivo confocal microscopy (IVCM) has revealed dysplastic cells, nuclear mitotic figures, and nests of whorled cells in the superficial stromal layer, distinguishing OSSN from corneal intraepithelial neoplasia (CIN).(18) Another study found that OSSN on IVCM was characterized by hyperreflective pleomorphic squamous cells in the anterior and middle epithelial layers, a well-defined border between neoplastic and normal epithelium, pleomorphic cells, and loss of sub-basal corneal nerves. OSSN lesions also included larger, irregular, hyperchromatic nuclei, bright spots in the basal cell layers (referred to as a “starry sky appearance”), and malignant cell infiltration into Bowman’s layer.
Ocular surface squamous neoplasia follows the 8th edition of the AJCC classification. Squamous cell cancer begins as carcinoma in situ before becoming invasive. Squamous cell carcinoma develops when the original squamous neoplasia breaches the basement membrane. Regional lymph node metastases and distant metastases are less common in conjunctival SCC compared to other squamous cell carcinomas, but a small percentage of patients succumb to the disease. (Table 2)
Topical chemotherapy drugs such as Interferon-α2b, mitomycin C, and 5-fluorouracil can treat the entire surface of the eye, preventing surgical problems such positive margins, scarring, and limbal stem cell deficit. IFNα2b, a cytokine released by immune cells, targets bacteria and viruses. Its antiproliferative, cytotoxic, antiviral, and antigenic effects may explain its
T1 Tumor <=5 mm in greatest dimension invades through the conjunctiva basement membrane without invasion of adjacent structures.
T2 Tumor >5 mm in greatest dimension invades through the conjunctiva basement membrane without invasion of adjacent structures
T3 Tumor invades adjacent structures (excluding the orbit)
T4 Tumor invades the orbit with or without further extension
T4a Tumor invades orbital soft tissues without bone invasion
T4b Tumor invades bone
T4c Tumor invades adjacent paranasal sinuses
T4d Tumor invades brain
mechanism. It can be used as an eye drop or subconjunctival injection. Topical IFNα2b has an efficacy rate of 80%-100%.
Although well-tolerated, topical IFNα2b is expensive and only available at compounding pharmacies, necessitating refrigeration. One to five cycles of 5-fluorouracil (5-FU) (1 month on, 3 months off) with a recurrence rate of 20% have been 100% effective. Ocular inflammation is reduced by cycling the medicine four times a day for four to seven days, followed by three weeks. 5-FU is less expensive than MMC and IFNa2b and has fewer side effects. Disadvantages include mild ocular discomfort and conjunctivitis. These adverse effects are mitigated by topical corticosteroids and preservative-free artificial tears. OSSN is effectively treated with topical mitomycin C. MMC works by DNA alkylation and RNA disruption. Its efficacy ranges from 80% to 100%. The concentration of MMC is either 0.02% or 0.04%. The higher concentration may be administered for one week, followed by a 2-3-week rest period, while the lower

Table 2. Squamous Cell Carcinoma - AJCC 8th edition Figure 1. OSSN management – Medical treatment for ocular surface squamous neoplasia - Monroy - Eye (2023) 37:885-893
concentration is typically administered for one month. It requires refrigeration. Although MMC resolves more rapidly than IFN, clinical remission and recurrence rates are comparable. MMC may induce superficial toxicity, loss of limbal stem cells, and ocular discomfort.
OSSN lesions are removed without contact. Limbus CIN and SCC should be eliminated with a 3-4 mm conjunctival margin. A wide conjunctival margin is crucial because clinically uninvolved tissue may contain dysplastic cells. The cornea is rinsed with abundant irrigation for 30-40 seconds after removing the epithelium from the basement membrane with pure alcohol. Once the alcohol loosens the cells, a Beaver blade or surgical sponge is used to scrape the corneal epithelium and pannus. This procedure must respect Bowman’s layer. Cryotherapy eliminates dysplastic cells at the conjunctival margins and the scleral bed through double or triple rapid freeze-thaw cycles. Excision may be followed by topical chemotherapy if the margins are positive or residual disease is present. Surgical resection could be concluded with amniotic membrane grafting. In the presence of squamous cell carcinoma, it is crucial to initiate adjuvant treatment with brachytherapy. Local invasion of the eye or orbit may require enucleation or exenteration by an oculoplastics surgeon.
In cases where a tumor is tightly adherent to the underlying structure or when UBM indicates invasion, it is imperative to administer an initial chemoreductive treatment. Disease staging may need sentinel node biopsy. If other therapies fail, radiotherapy may be employed. (Figure 1-5)




Melanocytic Lesion
Melanocytic nevi
Conjunctival nevi (CN) are the most common conjunctival neoplasms as well as the most common melanocytic lesions of the conjunctiva15. Conjunctival melanocytic nevi typically become noticeable during childhood. They appear as pigmented lesions on the bulbar conjunctiva, usually on one side. These lesions are well-defined and often contain small, clear cysts. The existence of these cysts within the stromal part of a nevus usually suggests that the lesion is not malignant. Caruncular melanocytic nevi are also common. Pigmented lesions of the tarsal conjunctiva usually represent intraepithelial acquired melanosis or melanoma, but they seldom occur at this site. Conjunctival nevi may be focal or diffuse but they are characteristically unilateral and unifocal.16
Amelanotic conjunctival nevi are melanocytic nevi without pigment, resulting in a pinkish appearance. This absence of pigmentation poses a challenge for clinical identification. The nevus may exhibit an increase in both pigmentation and size during puberty, making it more visible. Similar to cutaneous melanocytic nevi, conjunctival nevi experience alterations as they age. An inflammatory juvenile conjunctival nevus is a type of complex nevus that usually becomes noticeable during childhood or adolescence. It generally looks to grow quickly, which may indicate the presence of malignant transformation. Histologically, clusters of nevus cells are encircled and infiltrated by lymphocytes, plasma cells, and frequently eosinophils. An older patient, a large basal tumor diameter, intrinsic vasculature or prominent feeding vessels, and involvement or localization of the cornea in the palpebral, caruncular, or forniceal conjunctiva require surgical excision.16, 17
A blue nevus is an additional type of melanocytic nevi that can develop the conjunctiva. Clinically, it manifests as a nodule with a color ranging from dark blue-gray to blue-black. The melanocytes exhibit a spindle-shaped cell structure, like the nevus cells observed in the uveal tract. Additionally, these melanocytes tend to possess a considerable amount of melanin in their cytoplasm. Ocular and oculodermal melanocytosis, a condition more commonly observed in individuals with darker complexion, occurs beneath the conjunctiva, in the episclera, and in the sclera. It is characterized by the presence of clusters of dendritic melanocytes. The standard approach involves continuous monitoring, thorough examination using a slit lamp, and photographic record-keeping performed by an ophthalmologist.18 Benign nevi can


exhibit different appearances over time, depending on the individual’s hormonal condition. These changes can be observed during pregnancy as well as adolescence. Hormonal fluctuations can affect the visible pigmentation and size of a harmless nevus.16 Excision is often necessary for nevi located in the fornix, tarsal, or bulbar conjunctiva that exhibit substantial growth, neovascularization or feeding vessels, inflammation, or pigmentation alterations. (Figure 6-7)
Conjunctival melanosis refers to acquired pigmentation of the conjunctiva, which can be localized or diffuse, and occurs within the epithelium.
Conjunctival melanosis can be categorized into primary, secondary, and complexion-associated variants. Secondary melanosis and complexion-associated melanosis typically do not involve melanocytes proliferation but rather an increase in pigment production. PAM is characterized by melanocytes overgrowth, which increases the likelihood of cancer development. Understanding the terminology and procedures used in pathological diagnosis is crucial when considering the treatment of these abnormal growths.
Secondary acquired melanosis refers to the presence of more melanocytes in the conjunctiva as a reactive response to another conjunctival lesion, such as squamous papilloma or cancer, or underlying conjunctival inflammation.
Complexion-associated melanosis, also known as benign epithelial melanosis, racial melanosis, or primary conjunctival melanosis, is characterized by patches of brown pigmentation with irregular borders. This condition typically affects the bulbar conjunctiva and is commonly observed in individuals with dark skin pigmentation.
Primary acquired melanosis (PAM) is classified into two categories: PAM without atypia and PAM with atypia. PAM typically manifests as a single pigmented macule or patch on one side of the body in middle-aged individuals with fair skin. The lesion may remain stable, or undergo periodic fluctuations over several years. Clinically, it is not possible to distinguish PAM without atypia from PAM with atypia; only histological examination can differentiate between two lesions. Recommendations regarding the optimal timing for observation versus biopsy of PAM are subject to debate and disagreement. Nevertheless, clinical observations such as a larger lesions size (covering 3 clock-hours or more) and a position in the



caruncular, forniceal, or palpebral regions indicate a less favorable prognosis. PAM without atypia is defined by an elevated quantity of melanocytes that appear normal under microscopic examination. Severe cytologic atypia is characterized by several features, including increased cell division, clustering of cells, spreading of cells along the surface, enlargement of cells, a specific type of cell shape resembling epithelial cells, visible structures within the cell nucleus, and larger nuclei with intense staining. Immunohistochemical stains, such as Melan A, HMB-45, and MITF, when combined with a red chromogen, are effective in identifying and quantifying the growth of melanocytes. (Figure 8-10)
PAM with mild atypia poses a negligible, if not zero, chance of developing into a malignant condition. On the other hand, PAM with moderate or severe atypia and melanoma in situ has a considerable risk (about 10%-15%) of developing into melanoma.
Conjunctival melanoma (CM) is most frequently observed in individuals in their sixth decade of life, with an average age of diagnosis being 62 years. There is a slight tendency for CM to
occur more often in males, accounting for 59% of cases. Elderly patients typically exhibit more advanced disease and are at a greater risk for both deterioration of visual acuity and local recurrence. While there have been reports of cases in children, this phenomenon is extremely uncommon. CM typically develops in connection with pigmented skin lesions, such as pigmented actinic keratosis (PAM), cutaneous melanocytic nevus (C-MIN), or cutaneous melanocytic intraepidermal neoplasia (CMIL).
About 50%-70% of conjunctival melanoma originate from PAM with atypia; the other cases arise from a nevus or occur spontaneously. Melanomas typically present as nodules and can affect any part of the conjunctiva. The nodule may or may not have pigmentation. Amelanotic refers to a type of conjunctival melanoma that accounts for 15%-25% of cases. Conjunctival melanomas have a metastasis rate of 25% to regional lymph nodes, as well as to the lungs, liver, brain, bone, and skin. The mortality rate in these instances typically ranges from15% and 30%. Indicators associated with a more unfavorable prognosis in a clinical setting include:
• Location of the conjunctiva not involving the bulbar region (such as plica semilunaris/ caruncle, forniceal or palpebral conjunctiva)
• Tumor thickness has significantly risen, measuring more than 1.8 mm.
• The eyelid margin is affected by the tumor.
If there is a strong suspicion of melanoma, it is advisable to refer the patient to a surgeon with experience in removing and treating tumors of the surface of the eye. This is important since the patient’s prognosis is not good if the tumor is not completely removed. At times, an anterior uveal melanoma can extend beyond the sclera and appear as a mass on the outer layer of the eye or the conjunctiva, which can be mistaken for a primary conjunctival melanoma. When considering potential causes for a nonmobile pigmented or amelanotic episcleral nodule atop the ciliary body that has sentinel vessels but lacks surrounding PAM, it is important to include extrascleral extension of anterior uveal melanoma in the list of possible diagnoses. It is essential to conduct a thorough eye examination for any patient presenting with a conjunctival tumor, including gonioscopy and dilated ophthalmoscopy. Reactive pigmentation that mimics melanoma is often observed in persons with darker skin complexion who have conjunctival squamous cell carcinoma (SCC). At the time of presentation of CM, 98% of patients are symptomatic. The most frequent symptoms include a visible spot (77%), a lump (17%), ocular irritation (1%), and pain (1%).19
Immunohistochemical stains for melanocytes, such as Melan A, HMB-45, and MITF, can be useful in circumstances when a diagnosis is difficult. Furthermore, the discovery of tumor-specific biomarkers has improved the evaluation of conjunctival melanoma. For instance, alterations in the BRAF gene, found in 30%–50% of conjunctival melanomas, can serve as an indicator of metastasis. Identifying biomarkers of melanoma, as well as using targeted treatments against them, is crucial for treating a disease that has migrated beyond the ocular surface.
The treatment of conjunctival melanoma treatment depends on the size of the lesion. A surgeon with experience in conjunctival melanocytic lesions should perform primary excision to avoid recurrence. Some authors recommend excising the lesion en bloc without touching the tumor and only handling surrounding normal tissue. The removal of melanoma aims for clear margins of 3-4 mm. Subclinical disease is eliminated by cryotherapy of the adjacent conjunctival tissue. The excision deficit is measured after tumor removal. The Tenon’s fascia and conjunctiva are closed for reconstruction. Surgical sites that are too large for primary closure can be closed with an amniotic membrane. Tumor-free margins are possible with super thin partial sclerectomy of the scleral base and corneal alcohol epitheliectomy. If the margins show intraepithelial disease after surgery, topical mitomycin-C is often used as adjuvant ther-
apy. The entire ocular surface can be treated with topical chemotherapy for diffuse disease or large areas that cannot be surgically removed, especially in situ lesions. In the presence of positive margins carcinoma, it is imperative to initiate adjuvant treatment with brachytherapy. In the case of orbital invasion, exenteration is required and radiation administered if the tumor is large and locally advanced.
Sentinel lymph node biopsy for CM staging and management is controversial, but it may be a prognostic indicator. The routine use of sentinel lymph node biopsies can identify micrometastases and macrometastases, providing prognostic information and identifying patients who may benefit from targeted or immune-modulatory therapies. Like the treatment of primary CM, recurrences are treated with a variety of techniques either alone or in combination with complete resection, radiotherapy, or in advanced cases, exenteration.19
Lymphoma is a cancerous growth that originates from the abnormal reproduction of B or T lymphocytes, and occasionally natural killer cells (NK cells). It is classified into two main categories: Hodgkin lymphoma and non-Hodgkin lymphoma (NHL). Conjunctival lymphomas account for approximately 25% of all ocular adnexal lymphomas, with almost all (98%) of them being of B-cell lineage. The prevailing subtypes include low grade extranodal marginal zone (81%), follicular (8%), high grade mantle cell, and diffuse large B cell (3%) lymphoma.20, 21 Both noncancerous and cancerous growths of lymphoid cells can develop in the conjunctiva. The conjunctiva often contains mucosa-associated lymphoid tissue (MALT), which includes a few tiny lymphoid follicles that may easily be observed during a clinical examination in the normal lower fornix. Nevertheless, there is a possibility of abnormal growth of lymphoid tissue in the conjunctiva, even without any indications of inflammation. This excessive growth of lymphoid tissue can either be non-cancerous (reactive) or cancerous. From a clinical perspective, both benign and malignant lymphoid conjunctival lesions manifest as pliable, movable, salmon-pink growths with a smooth texture. These growths are typically found in the forniceal and bulbar conjunctivae. The problem can occur unilaterally (which is more prevalent) or bilaterally. There is a possibility that an orbital component may also exist.
Benign lymphoid hyperplasia is characterized by the excessive growth of lymphocytes. This growth is usually seen in a pattern that resembles follicles and is caused by the proliferation of multiple types of lymphocytes.
Biopsy is necessary to ascertain the nature of conjunctival lymphoid lesions, whether they are benign or malignant neoplasms. Due to the limited size of the biopsy specimen acquired, the evaluation of these lesions is constrained. Conjunctival lymphoid lesions are commonly assessed via histologic examination and immunohistochemistry. Immunohistochemistry analysis involves the application of stains to detect different types of antigens found in lymphocytes. If the sample tissue is enough for further analysis, flow cytometry and molecular genetic tests can also be conducted.
The differential diagnosis of conjunctival lymphoma encompasses various conditions, including benign reactive lymphoid hyperplasia, benign ocular surface tumors like pyogenic granuloma and papilloma, malignant tumors such as squamous cell carcinoma, foreign body granuloma, amyloid deposition, and chronic follicular conjunctivitis.
Subtypes of non-Hodgkin’s lymphoma can exhibit variations, such as mantle cell lymphoma (a type of B cell NHL), which occurs as a secondary disease in 50% of cases.
After being identified, the patient requires a comprehensive assessment and should be sent to a hematologist. Comprehensive staging may involve conducting a whole-body PET and CT

scan, or an MRI and bone marrow biopsy. The sensitivities of PET and CT are 85% and 70%, respectively. Furthermore, a hematologic screening is imperative for these patients.
The treatment of this condition involves a multidisciplinary approach, involving ophthalmologists, hematologists, and radiotherapists. Treatment options include surgical resection, cryotherapy, radiotherapy, systemic chemotherapy, or targeted anti-B-cell therapy (rituximab). External beam radiotherapy (EBRT) is the preferred treatment for managing slow-growing extranodal marginal zone lymphoma (EMZL) and follicular lymphoma (FL), but it is only used in 20% of patients with aggressive B or T cells. Usually, a dose of 20-50 Gy is administered, with the treatment being divided into 15 sessions. Using this therapeutic approach, 80% of individuals will not encounter any advancement or reappearance of symptoms within a 5-year monitoring period. Administering a reduced amount of radiation over two sessions has been proven to completely resolve conjunctival lymphoma.22
Chemotherapy is the main treatment for more aggressive types of lymphomas. It is highly effective in eliminating almost 75% of high grade B and T cell lymphomas. 22,23 However, it also has a higher level of toxicity. Chemotherapy commonly involves a combination of drugs, such as CVP (cyclophosphamide, vincristine, and prednisone) or CHOP (cyclophosphamide, hydroxydaunorubicin, oncovin, and prednisone).
Additional treatment options encompass the use of monoclonal antibodies such as Rituximab (targeting CD20) and Daclizumab (targeting CD25). These can be utilized if the appropriate B-lymphocyte antigens are present, and can be administered systemically either on their own or in combination with traditional chemotherapy, or as an injection directly into the affected area. A number of small studies have indicated that 75% of patients with isolated disease will not experience any progression or recurrence within one year after receiving intralesional Rituximab. Interferon-alpha, a form of local immunotherapy, has been reported as a viable treatment option for EMZL.
Approximately one-third of patients experience recurrence or progression within three years.24 Nevertheless, this also exhibits a greater frequency of occurrence and advancement rates comparable to surgical removal.
In general, the prognosis is favorable, as 90% of patients do not experience any progression or recurrence within one year of follow-up.
Lymphomas with low grades exhibit the least amount of progression, while diffuse large B cell and mantle cell lymphomas with higher grades follow. T cell lymphomas have the most unfavorable prognosis, as 50% of patients undergo progression or recurrence.22, 24 (Figure 11)
References
1. Milman T, Grossniklaus HE, Goldman-Levy G, et al. The 5th Edition of the World Health Organization Classification of Tumours of the Eye and Orbit. Ocul Oncol Pathol 2023;9:71-95.
2. Kaliki S, Shields CL. Uveal melanoma: relatively rare but deadly cancer. Eye (Lond) 2017;31:241-257.
3. Sjö NC, Heegaard S, Prause JU, von Buchwald C, Lindeberg H. Human papillomavirus in conjunctival papilloma. Br J Ophthalmol 2001;85:785-7.
4. Buggage RR, Smith JA, Shen D, Chan CC. Conjunctival papillomas caused by human papillomavirus type 33. Arch Ophthalmol 2002;120:202-4.
5. Saegusa M, Takano Y, Hashimura M, Okayasu I, Shiga J. HPV type 16 in conjunctival and junctional papilloma, dysplasia, and squamous cell carcinoma. J Clin Pathol 1995;48:1106-10.
6. MJ. M. Epithelial tumors of the conjunctiva. In: Holland EJ, editor. Cornea. Fourth edition. Edinburgh, Scotland: Elsevier; 2017. p. 410–26.
7. Rosa RH BR, Harocopos G, et al. . Ophthalmic pathology and intraocular tumors. San Francisco, CA: American Academy of Ophthalmology; 2011. p. 61–2.
8. Moyer AB, Roberts J, Olsen RJ, Chévez-Barrios P. Human Papillomavirus-Driven Squamous Lesions: High-Risk Genotype Found in Conjunctival Papillomas, Dysplasia, and Carcinoma. Am J Dermatopathol 2018;40:486-490.
9. Krachmer JH MM, Holland EJ. . Cornea: Fundamentals, diagnosis and management. 2005.
10. Karp CL, Scott IU, Chang TS, Pflugfelder SC. Conjunctival intraepithelial neoplasia. A possible marker for human immunodeficiency virus infection? Arch Ophthalmol 1996;114:257-61.
11. Basti S, Macsai MS. Ocular surface squamous neoplasia: a review. Cornea 2003;22:687-704.
12. Thomas BJ, Galor A, Nanji AA, et al. Ultra high-resolution anterior segment optical coherence tomography in the diagnosis and management of ocular surface squamous neoplasia. Ocul Surf 2014;12:46-58.
13. Ong SS, Vora GK, Gupta PK. Anterior Segment Imaging in Ocular Surface Squamous Neoplasia. J Ophthalmol 2016;2016:5435092.
14. Bianciotto C, Shields CL, Guzman JM, et al. Assessment of anterior segment tumors with ultrasound biomicroscopy versus anterior segment optical coherence tomography in 200 cases. Ophthalmology 2011;118:1297-302.
15. Shields CL, Alset AE, Boal NS, et al. Conjunctival Tumors in 5002 Cases. Comparative Analysis of Benign Versus Malignant Counterparts. The 2016 James D. Allen Lecture. Am J Ophthalmol 2017;173:106-133.
16. Folberg R, Jakobiec FA, Bernardino VB, Iwamoto T. Benign conjunctival melanocytic lesions. Clinicopathologic features. Ophthalmology 1989;96:436-61.
17. Levecq L, De Potter P, Jamart J. Conjunctival nevi clinical features and therapeutic outcomes. Ophthalmology 2010;117:35-40.
18. Oellers P, Karp CL. Management of pigmented conjunctival lesions. Ocul Surf 2012;10:251-63.
19. Shields CL, Shields JA, Gündüz K, et al. Conjunctival melanoma: risk factors for recurrence, exenteration, metastasis, and death in 150 consecutive patients. Arch Ophthalmol 2000;118:1497-507.
20. Ferry JA, Fung CY, Zukerberg L, et al. Lymphoma of the ocular adnexa: A study of 353 cases. Am J Surg Pathol 2007;31:170-84.
21. Sjö LD, Ralfkiaer E, Prause JU, et al. Increasing incidence of ophthalmic lymphoma in Denmark from 1980 to 2005. Invest Ophthalmol Vis Sci 2008;49:3283-8.
22. Baldini L, Blini M, Guffanti A, et al. Treatment and prognosis in a series of primary extranodal lymphomas of the ocular adnexa. Ann Oncol 1998;9:779-81.
23. Tanimoto K, Kaneko A, Suzuki S, et al. Primary ocular adnexal MALT lymphoma: a long-term follow-up study of 114 patients. Jpn J Clin Oncol 2007;37:337-44.
24. Cahill M, Barnes C, Moriarty P, Daly P, Kennedy S. Ocular adnexal lymphoma-comparison of MALT lymphoma with other histological types. Br J Ophthalmol 1999;83:742-7.
Edoardo Midena, Giulia Midena
The most common primary intraocular tumor in adults is choroidal malignant melanoma (this term generally includes both ciliary body and choroidal melanomas and will be used as such in this text). Its incidence is approximately 5-7 per million per year in the United States and Western Europe. In the United States alone, approximately 1200- 1500 new cases of uveal melanoma are diagnosed each year[1]. This malignancy occurs more frequently in middle-aged and elderly Caucasian patients, and is rare in populations with darker skin tones. Epidemiologic studies have shown a slightly increased incidence of uveal melanoma in populations with higher sun exposure, and these lesions are also more prevalent in patients with ocular or oculodermal melanocytosis (nevus of Ota)[1, 2]
Although uveal nevi are more common in patients with dysplastic nevus syndrome, the frequency of uveal melanoma in this population does not appear to be higher than the baseline. Unlike cutaneous melanoma, which has shown a five- to six- fold increase in incidence over the past decades, the frequency of uveal melanoma seems to have remained unchanged. Approximately 12% of all melanomas originate in the uveal tract. 80% of uveal melanomas occur in the choroid; 5- 8% are iris lesions; and 10-15% involve the ciliary body[3]
Making an accurate diagnosis of a posterior uveal tumor can be difficult. History and presentation vary; approximately 33% of patients with uveal melanoma are asymptomatic at the time of diagnosis. Patients may report flashing lights or scotomas. If a large uveal melanoma is present, symptoms may develop due to exudative detachment[3-5]. Patients with tumors near or within the macula may present with metamorphopsia. In cases involving the ciliary body, sentinel vessels are often observed. Some of these patients initially experience visual distortion due to astigmatism, which results from a growing ciliary body melanoma pressing against the lens[4]
Subjective findings are more useful for identifying a simulating lesion than for diagnosing uveal melanoma. Atypical findings for a choroidal melanoma include severe ocular pain, which is rare unless the uveal tumor has caused vision loss, ocular inflammation, glaucoma, or extraocular extension. Similarly, a history of systemic malignancy should be investigated. Patients with systemic hypertension, recent intraocular surgery, or collagen vascular disease are at higher risk of developing simulating lesions such as ruptured arterial microaneurysms, localized choroidal detachments, macular disciform lesions, and scleritis[4].
Melanoma is very rare in patients under the age of 20. An intraocular malignancy should be considered in the differential diagnosis for any patient with unilateral cataract or opaque media.
Lesions that most commonly simulate uveal melanoma include uveal nevi, choroidal he-


demonstrates hyperautofluorescence overlying the lesion corresponding to lipofuscin (orange pigment)
mangiomas, choroidal metastases, rhegmatogenous retinal detachments, and neovascular disciform lesions. Numerous other less common lesions can also imitate uveal melanomas, for example, retinal pigment epithelium (RPE) tumors, including RPE hypertrophy and hyperplasia, melanocytoma, choroidal detachment (particularly after cataract surgery), cysts, choroidal osteoma, inflammatory disease (such as tuberculomas, etc.), uveal effusion syndrome, leiomyoma, hemangiopericytoma, lymphoid lesions, and intraocular foreign bodies[4-6]. The appearance of fundus lesions on indirect ophthalmoscopy is often diagnostic. The major goals in evaluating posterior uveal tumors are to determine whether an intraocular malignancy is present and whether intervention is necessary. As discussed below, if a lesion is thicker than 4 mm and the media are clear, the diagnosis can often be made using indirect ophthalmoscopy alone. Similarly, the evaluation and management of flat tumors are straightforward. A flat, asymptomatic lesion without subretinal fluid is typically not serious and requires little additional evaluation beyond fundus photography. If a flat lesion has a diameter greater than 6 mm, fundus photography should be obtained, and the lesion should be followed. Ultrasonography is not useful for diagnosing lesions with a thickness of less than 1-2 mm but can be helpful as a baseline for serial evaluation. One of the most challenging diagnostic groups consists of pigmented tumors with a thickness between 1 and 3 mm. Differentiating a small melanoma from an atypical large nevus is very difficult and sometimes impossible. A combination of non-invasive diagnostic tests is used to evaluate posterior uveal melanomas masses, typically including indirect ophthalmoscopy, fundus photography, optical coherence tomography (OCT), fluorescein angiography, and ultrasonography. A brief review of the various lesions in the differential diagnosis of posterior uveal melanomas highlights the role of these diagnostic techniques as well as their limitations[4, 7-10]
Choroidal nevi
Choroidal nevi are usually flat or minimally elevated lesions, hyperpigmented, and almost always less than 5 mm in diameter. Most are asymptomatic but can rarely produce subretinal fluid or overlying retinal changes that may cause visual distortion. Characteristic flat, asymptomatic choroidal nevi should be documented during the initial visit with fundus photography and then monitored serially every 2 years without ancillary testing[4]
Uveal nevi may be covered by isolated or confluent light yellow or white drusen. Less fre-
quently, nevi can be hypopigmented, associated with subretinal neovascularization, surrounded by a hypopigmented, or exhibit changes in the overlying retinal pigment epithelium. Unlike mimicking metastatic lesions, hypopigmented nevi lack associated subretinal fluid and do not have a preference for the posterior pole. Subretinal neovascularization is a sign of chronicity[4, 11]. (Figure 1)
Less common causes of flat choroidal pigmentation include multiple choroidal nevi, which occur as a normal variant or as proliferations of uveal melanocytes and are rarely observed in patients with diffuse metastases. Finally, as discussed under choroidal melanocytomas, diffuse, benign, flat choroidal pigmented lesion scar may occur[12].
More thorough evaluation of suspected nevi is warranted if any of the following conditions are present[13]:
1. Visual symptoms (visual acuity < 20/50)
2. Elevated lesion, with a thickness above 2mm
3. Fluid detachment
3. Overlying orange pigmentation
4. Margin touching (or approaching) the optic disc
5. Ultrasound hollowness
6. Absence of halo
7. Absence of drusen
8. Basal diameter greater than 5mm.
Orange pigmentation, visible due to the contrast between lipofuchsin and melanin, is most commonly observed in melanomas[4,7,13]. It can be easily recognized by performing blue fundus autofluorescence. (Figure 2)
Nevi with orange pigment are more likely to progress into melanomas. As mentioned earlier, it is nearly impossible to differentiate atypical nevi from small melanomas with a thickness between 1 and 3mm. Fortunately, most small uveal melanomas (<3 mm in thickness and <10 mm in diameter) are asymptomatic, do not present subretinal fluid, and can be safely managed with observation until growth is documented. Fluorescein angiography is usually not helpful in differentiating small melanomas from nevi; however, it may be useful in diagnosing certain conditions, including choroidal hemangioma and subretinal hemorrhage. The accuracy of ultrasonography in differentiating atypical uveal nevi from melanoma is unclear. It is not reliable to diagnose melanoma based on ultrasonographic criteria alone unless the thickness exceeds 3 mm [14]. OCT is indeed helpful in diagnosing a small melanocytic lesion, and it clearly assesses the presence of fluid (perilesional serous retinal detachment) around it[13, 15, 16]. (Figure 3)

Retinal pigment epithelium hypertrophy and hyperplasia
Other flat and pigmented lesions can occasionally be confused with melanomas. Retinal pigment epithelium (RPE) hypertrophies present a halo, scalloped margins, lacunae, and usually exhibit much darker pigmented areas compared to melanomas or nevi. RPE hyperplasia occurs as a result of infection, trauma, or uveitis; these lesions are characterized by flat, black pigmentation with ragged margins[17] .
Choroidal melanomas
Making the correct diagnosis in suspected uveal melanomas depends on the observer’s experience, and the clinical characteristics. In most ocular oncology units, over 99% of tumors requiring therapeutic intervention can be correctly diagnosed. Fortunately, since it is nearly impossible to differentiate a small melanoma from a large atypical nevus, patients with small and indeterminate lesions with a thickness between 1 and 3 mm are usually managed with observation[5,9,18].
Very few physical findings are pathognomonic for the diagnosis or exclusion of a small uveal melanoma[9, 19]. Clinically, unless there are signs of activity, such as subretinal fluid or documented growth, it is nearly impossible to distinguish tumors that will grow from those that will remain stable for many years. As discussed above, the fluorescein pattern is not diagnostic, and with ultrasound, we cannot distinguish a potentially active small melanoma from a large atypical large nevus.
Some clinical features, such as subretinal neovascularization, drusen, and a hypopigmented surround, are signs of chronicity[13]. However, even when factors associated with chronicity are observed, lesions should still be carefully monitored. Moreover, a thorough evaluation of the retina with OCT can reveal a plethora of changes in its layers, which are characteristic of small melanomas and absent in pigment nevi. The presence of such changes in the retina should raise suspicion for a choroidal malignancy. cChanges detected on OCT include abnormal or shaggy photoreceptors, loss of the external limiting membrane, loss of the ellipsoid zone, abnormalities in the inner plexiform layer, and irregularities in the ganglion cell layer. The term “shaggy photoreceptors” refers to their irregularity and presumably the elongation of rods and cones, associated with the presence of newly accumulated subretinal fluid. According to various estimates, the accumulation of subretinal fluid occurs in 76–91% of choroidal melanomas[9,13]. (Figure 4)

The pigmentation of uveal melanomas is variable; intrinsic tumor pigmentation is usually present, although 25% of cases are amelanotic. Most melanomas are light to medium gray in color; moderately elevated black lesion (<4 mm) is more likely to be a melanocytoma or an extramacular disciform lesion, especially if significant vitreous hemorrhage is present. As mentioned earlier, orange pigmentation is quite common in melanomas. There are several clinical, ultrasonographic, and photographic features typical of medium (10-15 mm in diameter and/or 3-5 mm in thickness) and large uveal melanomas (more than 15 mm in diameter or more than 5 mm in thickness). Large uveal melanomas may have the typical collar-button or mushroom-shaped appearance that occurs when the tumor breaches Bruch’s membrane. This topography is almost pathognomonic for a uveal melanoma[4]. Retinal invasion is often associated with a collar-button configuration; on ophthalmoscopic examination, the surface of the melanoma above the collar button appears velvety brown. Often, when Bruch’s membrane is breached, either a tumor or a retinal blood vessel ruptures, resulting in a small localized vitreous hemorrhage. Rarely, a dense vitreous hemorrhage occurs when a uveal melanoma breaches Bruch’s membrane. A mass less than 5 mm thick is unlikely to rupture Bruch’s membrane, and in these cases, a dense vitreous hemorrhage is more suggestive of an extramacular or macular disciform process, although a melanoma must still be excluded. Eyes with large choroidal melanomas usually have an associated exudative retinal detachment. Sometimes, it is difficult to differentiate a rhegmatogenous retinal detachment from an exudative one. Four characteristics are helpful in distinguishing these conditions. First, retrolental detachments (except those associated with proliferative vitreoretinopathy) are almost never rhegmatogenous; if the retina is easily visible on routine slit-lamp biomicroscopy, the detachment is almost always secondary to tumor or inflammation. Secondly, exudative detachments present displaced subretinal fluid margins: the fluid accumulates inferiorly when the patient is in vertical position and superiorly when the patient’s head is tilted downward. Thirdly, the subretinal fluid associated with melanoma is usually fairly clear, and the retinal marking is distinct. These exudative detachments are often overlooked or mistaken for retinoschisis by an inexperienced observer. This clarity of retinal details can also be observed in some long-standing rhegmatogenous detachments. It is quite common for smaller melanomas to present subretinal fluid just above the tumor or visible only in the lower fundus; this is more easily detected through indirect ophthalmoscopic examination to identify elevated retinal vessels. Fourthly, patients with exudative detachment do not have retinal holes (although a careful examination of the fundus will detect retinal breaks in about 6% of patients with uveal melanoma, an incidence comparable to that of the general population). (Figure 5)
A variant of the more common globular-shaped choroidal melanoma is the diffuse uveal melanoma; this type has a higher tendency for extraocular extension. The definition of these lesions is that they involve at least 25 % of the uveal tract and have a thickness of less than 5 mm[4]
Ultrasound evaluation is the most useful diagnostic test in assessing patients with elevated uveal mass lesions, especially those with a thickness greater than 3 mm. Performing and interpreting ultrasound tests is a skill that requires experience; for beginners, recognizing patterns is a good first step in differentiating choroidal lesions. In A-scan echography, the reflectivity of the tumor is medium to low. Vascular pulsations can often be observed during the actual B-scan test[10,14]. (Figure 6)
As mentioned earlier, the diagnostic accuracy of fluorescein angiography in uveal melanoma cases is less than 50%. Fluorescein angiographic findings suggestive of a choroidal melanoma include an intrinsic vasculature, “hot spots” (initially point-source leakages that become diffuse over time), vascular leakage, and fluorescence blockage due to orange pigment[4]. Both


computed tomography (CT) and magnetic resonance imaging (MRI) generate images of uveal melanomas and simulate lesions. On MRI, the T1 and T2 parameters of uveal melanoma are relatively characteristic due to the free radicals of melanin; typically, these lesions display high signal intensity on T1-weighted images and low signal intensity on T2-weighted images. Nevertheless, the appearance of the image may vary depending on the degree of pigmentation and the presence of areas of necrosis or cavitation. Currently, both MRI and CT are much less cost-effective than ultrasonography and do not provide more information for the diagnosis of uveal melanoma[4]
Choroidal metastasis
Differentiating between a uveal metastasis and a primary uveal melanoma can be difficult. Approximately 6-10% of patients with documented uveal melanomas have previously had another treated systemic malignancy[20]
Metastatic deposits in the uveal tract may be the first sign of a systemic malignancy in about 50% of patients with documented choroidal metastases. The most common primary tumors that secondarily involve the choroid are breast, lung, kidney, gastrointestinal tract, and genitourinary tumors. In over 80% of lung and renal tumors, the ocular lesion is the first manifestation of malignancy. In contrast, more than 90% of patients with breast metastases to the uvea have a history of treatment for the primary tumor[20]
Metastatic choroidal tumors are amelanotic, usually involving the posterior pole (especially the macula), and are associated with subretinal fluid. About one-quarter of cases of uveal tract metastases are bilateral and/or present as multiple tumors in the eye. Metastatic deposits are far more common in the uvea than in the optic nerve, retina, iris, ciliary body, and vitreous[4]. The mushroom or collar-button configuration associated with a uveal melanoma is almost never seen with metastases[20]. Metastases do not have intrinsic tumor pigment; however, changes in the overlying retinal pigment epithelial may produce hyperplastic pigmentation. The clinical pattern of different histological types of metastatic tumors is not diagnostic. Metastatic breast carcinomas to the uveal tract often have a “peau d’orange” pattern, and metastatic foci are rarely large. The patterns on both B-scan and A-scan echography are distinctive and differ from those of a uveal melanoma. A solid choroidal tumor lacks the typical acoustic quiet zone, choroidal excavation, or orbital shadowing usually observed in


choroidal melanomas. The quantitative A-scan pattern is also distinctive. The reflectivity is medium to high; often, the posterior portion of the tumor pattern extends towards the sclera, a finding sometimes referred to as a negative angle kappa. Key features of OCT include an irregular (“lumpy bumpy”) anterior contour (64%), anterior compression of the overlying choriocapillaris (93%), and posterior shadowing (86%). The “lumpy bumpy” surface contrasts with melanoma and nevi, which shows a smooth domed surface. Fluorescein angiography is not particularly helpful in establishing a diagnosis in these patients. The plasma carcinoembryonic antigen (CEA) level is elevated above 10 ng/ml in approximately 50% of patients with uveal metastases, compared to almost none in patients with uveal melanomas[4,20]. (Figure 7)
Choroidal hemangiomas may present as solitary focal lesions or as a diffuse process, often in association with Sturge-Weber syndrome. Typically, focal lesions are moderately elevated (2 to 5 mm) and have pink-orange color, with subretinal fluid above. Some consider fluorescein angiography pattern diagnostic; the lesion is usually characterized by early lobular filling of the choroidal vessels in the tumor area before the retinal vessels fill. The ultrasonographic pattern is diagnostic. B-scan appearance is quite similar to that of a metastasis; a choroidal hemangioma appears solid without choroidal excavation, acoustic quiet zone, or orbital shadowing. On A-scan, the lesion has uniform high reflectivity[21,22]. (Figure 8)
As discussed previously, rhegmatogenous retinal detachment, RPE hyperplasia, and RPE hypertrophy can all mimic a melanoma; however, these conditions can almost always be differentiated based on indirect ophthalmoscopy findings alone.
A melanocytoma that does not involve the optic disc can be difficult to diagnose; a uniform jet black color is more consistent with a diagnosis of melanocytoma than uveal melanoma. Rarely, melanocytomas are found in children and involve the choroid diffusely[12]
A choroidal osteoma can resemble a metastatic tumor or an amelanotic melanoma upon ophthalmoscopic examination. Clinically, choroidal osteomas are amelanotic and relatively flat, with an irregular surface. On fluorescein angiography, there is often a circumferential capillary tuft area. Intralesional calcium is visible on ultrasonography or CT scans. Although most pa-

tients initially have had good vision, almost half eventually develop poor vision due to retinal atrophy or subretinal neovascularization. Choroidal osteomas usually occur in young females (more than 80%), and are located peripapillary. Occasionally, patients develop these lesions in an area of previous uveitis, and one-third of cases are bilateral[23]. (Figure 9)
Choroidal detachments, especially those following cataract surgery, can be confused with melanomas. Although these usually occur after prolonged hypotony and involve a large area of the choroid, they may be either focal or diffuse. More commonly, they dissipate within 6 weeks; on fluorescein angiography, the lesion does not show an intrinsic vascular pattern. Ultrasonography is not diagnostic; the A-scan or B-scan patterns of focal lesions can mimic melanoma[24]
Posterior scleritis can simulate an amelanotic melanoma. Most patients are female, and this condition is often associated with rheumatoid disease. Patients experience deep, aching pain, especially during ocular versions. The ultrasound pattern, which often shows fluid in Tenon’s space, is typical. Clinically, it can be associated with an exudative detachment over an amelanotic lesion with associated choroidal folds. Occasionally, an anterior extension of the scleritis is noted.
A wide variety of other lesions can simulate uveal melanoma[4,24].
The management of uveal melanomas is mainly conservative. The two most important clinical questions are: at what stage in the natural history of a uveal melanoma does it develop the ability to metastasize, and when is ocular intervention necessary to prevent the development of widespread disease? In other words, what is the most effective form of treatment for a given uveal melanoma?
Approximately 1% of patients with uveal melanoma present with both ocular and systemic disease simultaneously. It is likely that many more patients have microscopic disease, but we are unable to detect it with current imaging and blood tests. Unfortunately, 30-50% of the patients will develop metastases within 5 years of treatment. The most common initial presentation of metastases is in the liver; approximately 60-70% of patients initially develop
liver metastases. Therefore, abdominal ultrasound and a biochemical liver function tests are considered adequate. Usually, these patients experience right upper quadrant pain, a feeling of fullness, tenderness, nausea, vomiting, and weight loss. Other common presentations of metastatic uveal melanoma include subcutaneous nodules, lung disease, bone involvement, and central nervous system disease[4,25]
Conservative Treatment
Before the advent of radiation therapy, the elective method for treating uveal melanoma was enucleation. Recent randomized studies have definitively demonstrated that patients treated with radiation therapy and ocular enucleation have statistically similar survival rates. Today, most cases are treatable with brachytherapy[26]. This technique aims to induce the regression and the consecutive scar atrophy of the neoplasm through the placement of scleral contact plaques containing x or γ-emitting seeds. Historically, the first application of radioactive material for the treatment of choroidal melanoma is attributed to Moore, who in 1930 used Radon radioactive seeds. Subsequently, significant contributions were made by Stallard and Foster initially, t and later by Lommatzsch, who standardized the use of Cobalt and Ruthenium plaques for the conservative treatment of choroidal melanoma[4]. Actually, the most commonly used isotopes are Ruthenium-106 and Iodine-125. In 1987, Iodine-125 was chosen as the standard reference isotope within the COMS (Collaborative Ocular Melanoma Study)[26,27] In addition to brachytherapy, intraocular irradiation with accelerated particles and stereotaxic radiotherapy are also used in the treatment of uveal melanoma.
Brachytherapy
Therapy with radioactive plaque requires accurate localization of the tumor. For this reason, a corneal transilluminator is placed on the cornea; the tumor casts a scleral shadow outlined by marks to delineate the lesion’s margins. 5-0 Dacron sutures are used to attach an identical carrier (a “dummy” plaque) without the radioactive isotope to the scleral area overlying the tumor. The position of the carrier is then reconfirmed using point-source transillumination and indirect ophthalmoscopy; this allows the placement of sutures that will secure the actual plaque in situ while minimizing radiation exposure for the surgical team. All Iodine-125 plaques are custom-made; the tumor must be located at the exact center of some plaques, while other plaques are designed so that tumoricidal radiation extends a few millimeters laterally from the plaque edge. Similarly, some plaques are constructed so that the isodose radiation lines are quite asymmetric; the plaque cannot be randomly placed on a tumor. Typically, an apical dose of 85Gy is used to treat uveal melanomas; the plaques usually remain in situ for 4 to 7 days to deliver this dose. In many cases, due to the tumor’s location the removal of an extraocular muscle is required to provide adequate radiation.
A retrospective review of the global literature demonstrates that over 85% of uveal melanomas treated with brachytherapy irradiation were successfully controlled without the need for enucleation[4,26].
Charged particle irradiation
Proton beam irradiation is commonly used in the treatment of uveal melanomas. Charged particle irradiation offers four potential advantages over brachytherapy for uveal melanomas. The facilities associated with this technique are expensive to build and maintain, and require technically sophisticated support staff. Secondly,external complications caused by the passage of the radiation beam through normal tissue on its way to the tumor are sometimes
more frequent than the similar adnexal complications associated with plaques; these complications are usually minor. Thirdly, depending on the relative role of choroidal and retinal vascular closure in melanoma destruction, the higher dose delivered by a radioactive plaque to the tumor base, and thus to the basal vessels, might be advantageous compared to the uniform radiation dose of charged particles[4]
The indications and contraindications for charged particle irradiation of uveal melanomas are still being developed.
The treatment of uveal melanomas with charged particle irradiation involves tumor localization with 2.5 mm tantalum marker rings, treatment planning, and irradiation. The tumor and a 2 mm margin of normal uvea and retina are included in the radiation field. The tumor is localized using both diffuse corneal transillumination and point-source transillumination with indirect ophthalmoscopy. Marker rings are usually placed on the sclera approximately 2.0 mm from the tumor margins. A computer program is used to develop the treatment field.
The main effect of ocular irradiation is to destroy the reproductive integrity of the tumor; tumors rarely regress completely. (Figure 10)
In cases of large series, after successful treatment, tumors regress to approximately 40% of their pretreatment volume; only 10% of tumors entirely disappear during long-term follow-up. Direct radiation damage to the tumor, or indirect damage resulting from radiation-induced vasculopathy that decreases tumor perfusion, destroys the neoplasm[28]. Although there are some immediate effects of radiation on a tumor, most evidence of radiation-induced tumor damage is delayed. DNA errors are induced in the cell at the time of treatment. These errors manifest as tumor destruction when the cells enter mitosis; since the intermitotic phase of melanomas is variable and often prolonged, evidence of tumor shrinkage is usually delayed by 3 to 18 months. Tumors that have shown rapid growth seem more likely to regress rapidly compared to slower-growing melanomas; however there is some evidence that patients with fast-regressing melanomas have a worse prognosis.

After any form of alternative irradiation for uveal melanoma, five characteristics indicate the tumor’s response. The most frequent early finding is the loss of subretinal fluid. Subretinal fluid loss usually occurs after treatment; however, in 10% of cases, there is a transient increase in subretinal fluid not associated with ongoing tumor activity. In fact, regressing tumors produce vasoactive and inflammatory humoral factors that result in transiently fluid increase. In treated melanomas that have a transient increase in subretinal fluid and later show a decrease in tumor size, the fluid is resorbed in the first 12-15 months after treatment. Unfortunately, while transient macular detachments associated with exudative detachment in uveitis have a good prognosis for visual recovery, long-standing exudative macular detachments associated with tumors often result in permanent central visual loss[28]
The second clinical sign of radiation response is tumor thinning. There is a tendency for continuous tumor shrinkage over the first 2-4 years after treatment[28]
Quantitative A-scan ultrasonography is the most accurate method to demonstrate changes in tumor height; however, as previously discussed, there are limitations to the accuracy of this technique. After irradiation, changes in the ultrasound pattern occur, most notably the loss of vascularity and an increase in internal reflectivity. While changes in the ultrasound pattern are common after treatment, they are not universal. Finally, the clinical appearance of a successfully irradiated melanoma is characteristic. These lesions develop a superficial appearance resembling charcoal. Usually there is loss of normal retinal and choroidal vascularization in the area, with changes in the RPE, and a decrease in tumor thickness. It is not uncommon to have minimal or even no evidence of tumor shrinkage after radiation therapy; unless there is definite enlargement (at least 1-2 mm) in sequential ultrasound examinations or serial fundus photographs, the treatment is not considered a failure.
The follow-up schedule after any form of radiation therapy usually involves an ophthalmologic and systemic evaluation every 6 months.
Post-irradiation Complications
Conservative radiotherapy can affect almost every structure of the eye, causing several side effects that may require a specific management[29]
The pattern and timeline of radiation-induced complications vary. Eyelash loss and conjunctival and eyelid erythema become evident within the first 6 weeks after charged particle irradiation. Radiation-induced cataracts develop in 6-12 months if most of the lens is included in the high-dose irradiation region or the high-dose region for brachytherapy.
Radiation retinopathy, better defined as radiation chorioretinopathy, is one of the major complications following ocular irradiation[30,31]. Retinopathy is usually characterized by areas of capillary non-perfusion, cotton-wool spots, hemorrhages, microaneurysms, and exudates. Optic neuropathy has a typical appearance with early changes including flame hemorrhages and edema of the nerve-head; later, atrophy occurs with loss of normal disc microvasculature. Radiation retinopathy occurs slightly earlier with charged particle irradiation compared to radioactive plaque therapy, with an average onset time of 20 months post irradiation. (Figure 11)
In particular, OCT evaluation shows that radiation maculopathy is characterized by edematous changes in its early stages (cystoid macular edema) and/or ischemia and atrophic changes in the macular area in more advanced stages. Currently, there are no defined guidelines for the treatment of radiation maculopathy, and a clinical trial (AL protocol) is underway to assess the role of intravitreal therapy[31]. (Figure 12)
A serious complication of ocular irradiation is secondary glaucoma. Post-treatment neovascular glaucoma, which occurs in about 10% of patients with large melanomas, develops as a complication of both the radiation dose and tumor size. This complication can be difficult to

Figure 11. Color fundus photography showing a lasertreated radiation chorioretinopathy, characterized by chorioretinal atrophy, ischemia, ghost vessels, cotton wool spots, exudates and retinal hemorrhages; hemorrhages and exudates involve both the macular region (radiation maculopathy) and the optic nerve (radiation optic neuropathy)

Figure 12. Macular optical coherence tomography showing cystoid macular edema with limited subfoveal neuroretinal detachment secondary to radiation maculopathy
diagnose since the neovascularization has a much greater predilection for the angle of the anterior chamber than for the anterior surface of the iris. In many of these cases, glaucoma can be managed with steroids, glaucoma medications, and retinal ablation (panretinal photocoagulation) procedures[29]
Enucleation is the recommended therapy for numerous uveal melanomas. It should be used in patients who, after giving informed consent, request the removal of the eye. It is also optimal for patients whose melanoma involves more than 40% of the ocular volume or over 50% of the ocular circumference. Moreover, if the melanoma is associated with significant neovascularization or the eye is blind, enucleation should be performed[4]. The surgical procedure implies performing a 360° limbal peritomy. The quadrants are gently opened to isolate the muscles. The four rectus muscles are isolated and detached. Enucleation scissors are placed in the medial orbit; the blades are positioned around the optic nerve, which is severed. After enucleation, the eye should be carefully examined in the operating room. Once hemostasis is achieved, an implant is placed in the orbit. The largest implant size compatible with the patient’s orbital anatomy is used; in adults, a 20 or 22 mm sphere is inserted. After suturing the muscles and placing the sphere in the orbit, Tenon’s capsule and the conjunctiva are closed. A conformer is placed in the eye socket[4]
There are very few indications for orbital exenteration in uveal melanoma, even when focal extraocular extension is present. If diffuse extraocular extension is present, exenteration is indicated to remove the tumor, provided there are no metastases. A complete metastatic evaluation is performed prior to exenteration. Exenteration can be performed using either lid-sparing or non lid-sparing techniques[4]. The surgical procedure involves, if the eyelids are to be preserved, making a skin incision on the upper and lower eyelids, approximately 2 mm from the eyelash margin. The skin is mobilized, and a myocutaneous flap is raised toward the orbital rim in all directions. If the eyelids are to be sacrificed, an incision is made just inside the orbital rim and carried down to the orbital rim for 360°. The orbital rim is incised with a scalpel and freer elevators are used to undermine the periosteum for 360°. Scissors are used to cut the medial and lateral canthal tendons. The periosteum is elevated to the orbital apex, and the orbital contents are dissected and removed using curved scissors. Hemostasis is achieved with cautery to obliterate flow in the ophthalmic artery. If the eyelids is removed, the socket is repaired using a temporalis muscle flap. If the eyelid skin is preserved during exenteration, the eyelids are sutured together, and pressure is applied to the skin to force it into contact with the orbital walls The orbit is packed with gauze and antibiotic ointment for approximately 7 days, after which pressure and packing are gradually decreased[4]. The cosmetic outcome achieved with any form of orbital implant after exenteration is limited.
Metastatic detection protocols are performed every 6 months following conservative treatment, enucleation or exenteration. These protocols include liver function tests, physical examinations, and ultrasound screening of the liver.
Uveal melanoma metastases are usually first identified in the liver. The peak incidence of metastases occurs within the first 24-36 months after treatment. Unfortunately, like breast carcinoma, uveal melanoma can metastasize even 30 years after treatment, needing lifelong follow-up for all patients. Single-agent or combination chemotherapy regimens have shown rather poor outcomes in controlling visceral metastatic melanoma. Recently, the FDA approved Tebentafusp, a bispecific antibody engaging T cells with gp100 on HLA-A*02:01, as the first drug in its class specifically designed to treat metastatic uveal melanoma[32]
The management of choroidal metastases depends on the patient’s overall health, the presence or absence of central nervous system involvement, and the status of chemotherapy [20]. Therapeutic decisions must be made collaboratively with the patient’s oncologist, after a comprehensive metastatic evaluation, including brain MRI or CT scans, which are performed when ocular metastases are diagnosed. In most cases, the presence of metastatic choroidal disease is a highly unfavorable prognostic sign; most patients die within 6 months of diagnosis. Some patients with isolated choroidal metastases survive for several years following diagnosis. There are five treatment options for most forms of choroidal metastases: observation, chemotherapy, irradiation, laser therapy, and enucleation. Enucleation is recommended only when an eye with metastatic disease causes pain. Choroidal metastatic foci respond to systemic chemotherapy similarly to metastases in other body sites[20]. chemotherapy is probably the first-line treatment for choroidal metastases. After treatment for choroidal metastases, some tumor residue usually remains, and changes in the overlying retinal pigment epithelium are often present. When multiple uveal metastases are unresponsive to chemotherapy or various systemic treatments have failed, and both the choroidal and systemic tumors pro-
gress, external beam photon irradiation is indicated. Prior to radiation therapy, brain imaging studies are indicated. If the patient has a chance of long-term survival, minimizing radiation complications is important. Patients with multiple or diffuse choroidal metastases often do not benefit from external beam photon irradiation of localized, invasive radiation using either radioactive plaques or charged particle therapy. In cases where the lesion is single, unilateral and localized to the posterior pole, photodynamic therapy (PDT) is performed. The overall success rate for treating metastatic choroidal tumors is approximately 75%. Visual acuity is usually preserved if it is better than 20/200 at the outset; lesions causing a retrolental detachment or diffuse tumors surrounding the disc have a poor visual prognosis[20].
Choroidal hemangiomas require treatment when associated exudative detachment impairs vision. Treatment can be difficult for diffuse hemangiomas, like those often linked with Sturge-Weber syndrome. Treatment options have included external beam irradiation or beta-blockers systemic therapy. More recently, a targeted approach using brachytherapy has been proposed. Circumscribed choroidal hemangiomas respond slowly to laser therapy (PDT); frequently the fluid does not dissipate for at least 3 to 6 months after treatment[33]. Often choroidal hemangiomas require up to three treatment sessions to obliterate fluid and restore good vision[22]. A successfully treated focal choroidal hemangioma is usually not destroyed, but the subretinal fluid resorbs. In cases where choroidal hemangiomas are not responsive to PDT, treated with brachytherapy with subsequent resorption of subretinal fluid[34]
Retinal neoplasms are relatively few. Retinoblastoma is the most common malignancy, and it is a clinical condition requiring a multidisciplinary approach; it will be addressed separately. Metastatic lesions involving the retina are quite rare, much less common than metastases of the uveal tract. Retinal and RPE hamartomas occur, and both neoplasms and malformations of the retinal vasculatures and the pigmented epithelium have been reported. Below, retinal tumors and simulating lesions that are important, mainly in adults, are discussed.
Von Hipple first described retinal vascular tumors in 1904; Lindau observed their association with cerebellar tumors in 1926. In addition to central nervous system (CNS) findings, both visceral carcinomas and cysts occur as part of this syndrome. Renal cell carcinoma, pancreatic carcinoma, pheochromocytoma, islet cell tumor, and meningiomas have been reported in association with the syndrome, along with cysts in the pancreas, kidney, epididymis, liver, lung, adrenal glands, bone, omentum, and mesocolum[35]
Isolated retinal hemangioblastomas (angiomatosis retinae, capillary hemangiomas, or von Hipple lesions) or those associated with systemic and CNS findings (von Hipple-Lindau syndrome) occur as either a sporadic, isolated, nonheritable condition or as an autosomal dominant disease. Most patients with von Hipple-Lindau syndrome have a positive family history. The most common initial presentation is decreased vision in the second or third decade of life. Less frequently in the von Hipple-Lindau syndrome, the presenting sign may be CNS involvement or systemic carcinoma; visceral cysts and angiomas are usually symptomatic. Retinal lesions occur in around 33 to 50% of patients with von Hipple-Lindau syndrome. The gene for this disease appears to be located on chromosome 3[35, 36]. The clinical appearance of retinal angioma, especially in endophytic tumors protruding from the inner retina into

the vitreous, is usually diagnostic. These lesions are usually pinkish with obvious arterial feeder vessels. Bilateral involvement is common in both isolated retinal angiomas and von Hipple-Lindau syndrome. Usually, multiple lesions of different sizes are present. Fluorescein angiography reveals rapid perfusion through the feeder vessels, with rapid filling and staining of the hemangioblastoma[36]. Less commonly, an exophytic process appears as a pale gray lesion without an obvious feeder vessel; such a lesion can be identified using fluorescein angiography. Rarely, a von Hippel lesion can mimic a diabetic microaneurysm. Another rare presentation includes an exudative detachment and a large pinkish red hemangioblastoma on the optic disc. These juxtapapillary exophytic capillary hemangiomas may occur in isolation or may be part of von Hippel-Lindau syndrome. Fluorescein angiography can detect lesions before they become clinically evident. (Figure 13)
Other retinal vascular malformations or tumors usually do not have obvious feeder vessels, although feeder vessels are occasionally seen in retinoblastomas and, even less commonly, in melanomas. In every patient with a retinal angioma, computed tomography (CT) or magnetic resonance imaging (MRI) studies of the central nervous system (CNS) and the body should be performed. A brain MRI should be performed to determine whether CNS hemangioblastomas are present; although these tumors are more common in the cerebellum, they can occur in the medulla, other areas of the brain stem, the cerebrum, the optic chiasm, the optic nerve, and the spinal cord. Abdominal CT scans or ultrasound should be performed to determine if there are angiomas, malignancies, or cysts. The choice of ocular therapy depends on the size and location of the retinal angioma and the presence or absence of overlying fibrosis and hemorrhage[36]. Many small lesions (less than 1.5 mm in diameter with minimal elevation) show little growth on serial evaluation. Lesions smaller than 4.5 mm in diameter and with 1.0 mm in elevation can usually be treated with argon laser photocoagulation. However, particularly for thicker lesions, adjunctive cryotherapy is often necessary. Usually, both the tumor and the supplying vessels regress.
Treatment complications are more common in lesions with extensive overlying vitreous fibrous reaction; in such cases, the possibility of macular pucker or either exudative or rheg-
matogenous detachment is significant. Small lesions without these associated findings generally do well; large lesions, especially those on the disc, have a poor visual prognosis. New retinal angiomas can occur. Consequently, patients require lifelong serial evaluations. Mortality in this syndrome is usually due to CNS lesions or, less commonly, visceral malignancies.
Acquired retinal hemangiomas can simulate an isolated von Hippel lesion but they almost never have feeder vessels. They are yellowish or orange red, and often exhibit both exudate and hemorrhage. Usually, these lesions are peripheral and have associated exudate and intraretinal hemorrhage. If these lesions remain stable, no treatment is required. If the tumors progress or produce an exudative detachment, cryotherapy or diathermy is usually effective. A retinal cavernous hemangioma is an unusual retinal vascular malformation that can occur alone or in association with other CNS and systemic processes. Clinically, these lesions often appear as multiple sacculated aneurysms along the course of a retinal venule. These tumors do not grow and are not associated with subretinal fluid. Occasionally, fibrotic change may develop over the tumor’s surface; it has been described as forming a grape-like cluster with minimal elevation. Most patients with retinal cavernous hemangiomas do not require ocular therapy. Approximately one-third of patients show evidence of vascular pathology in the CNS.
Astrocytic hamartoma of the retina can occur as an isolated finding or as a part of tuberous sclerosis or neurofibromatosis. These lesions enlarge over time without evidence of calcification until late childhood. Fluorescein angiographic findings often reveal multiple vessels. If the child has tuberous sclerosis, other systemic findings may include adenoma sebaceum; shagreen patches, most often found in the lumbar area; cutaneous ash leaf lesions, easily visible under Wood’s light; and subungual fibromas[4, 37]. Most patients with tuberous sclerosis are intellectually disabled. The mulberry retinal pattern is very rare in young children; calcification is not present until the child is at least 8 years old. Occasionally, a hypopigmented iris spot may be an early sign of tuberous sclerosis. Massive retinal gliosis is another condition that very rarely can mimic an intraocular neoplasm[4]. (Figure 14)
George Coats described six cases of retinal vascular malformation and reviewed 14 others from the literature in 1908. Initially, he divided his cases into three groups. Group 1 had no vascular hemorrhagic changes, Group 2 showed multiple retinal vascular abnormalities with hemorrhages but without inflammation, and Group 3 had both angiomas and arteriovenous communications.
The spectrum of syndromes that Coats initially included in his description would encompass Leber’s miliary aneurysms, Reese’s telangiectasia, von Hippel’s disease, racemose aneurysms, and other malformations[38]. Currently, most ophthalmologists limit the diagnosis of Coats’ disease to entities that present retinal vascular abnormalities with telangiectasia and exudation. The exudation from vascular abnormalities causes a yellowish tumefaction that can simulate a neoplasm. More than 95% of cases are unilateral, with a strong male predominance. This condition is not hereditary. Two variants of Coats’ syndrome can simulate a tumor. In children under 3 years old, Coats’ syndrome can mimic a retinoblastoma; and in adolescent or older patients, the exudate associated with Coats’ syndrome can be confused with a metastatic uveal tumor or an amelanotic melanoma. In very young children, Coats’ syndrome

Figure 14. Color fundus photography (A) of astrocytic hamartomas. Blue-autofluorescence (B) shows hyperautofluorescent spots. Linear SD-OCT (C, D, E, shows hyperreflective thickening of the retinal nerve fiber layer RNFL with internal moth-eaten optical empty spaces and posterior dense optical shadowing.
usually presents as a total retinal detachment. The subretinal exudate is yellowish, in contrast to the white or pink color seen in retinoblastoma[38]
Examination often reveals telangiectatic changes in the peripheral retina. High-resolution thin-section CT evaluation of Coats’ syndrome in a child under 4 years old never shows intraocular calcification. In contrast, intraocular calcification is almost uniformly present in retinoblastomas with a thickness greater than 5 mm. There is a considerable variation in the presentation patterns and clinical course of Coats’ syndrome. Most patients are either under 4 years of age in the presentation, or over 10 years old. The majority of untreated young children develop retinal detachment. Generally, patients under 3 years old have more complications, and many of these patients eventually require enucleation of the affected eye. The choice of treatment in Coats’ syndrome depends on the ocular status and the patient’s age at the time of diagnosis. Although there is basically no chance of preserving vision in these eyes, the retina remains attached after treatment, and consequently cosmetic outcomes are better than if the eye were removed and a prosthesis implanted[4, 38] .
In older patients, the first symptom in Coats’ syndrome is usually a decrease in vision or visual distortion due to macular exudation with peripheral telangiectasia. These cases are managed with photocoagulation or cryotherapy of the peripheral retinal telangiectasia. The resorption of subretinal exudate is very slow, and usually takes between 3 and 12 months after successful treatment. Rarely, after adequate treatment, new retinal telangiectases develop or become apparent in other areas of the peripheral fundus. Despite the rarity of recurrence, frequent examinations are necessary, and disease reactivation is observed even up to 5 years after successful treatment. Isolated cases of Coats’ syndrome in the macula have been reported in adults, but Coats’ syndrome usually does not fall within the differential diagnosis of ocular oncologic problems. Occasionally Coats’ syndrome occurs alongside other conditions, including retinitis pigmentosa and various systemic syndromes[4,38]. (Figure 15)
The combined hamartoma of the retina and retinal pigment epithelium is a rare benign lesion found in the macula, juxtapapillary, or in the periphery that is commonly diagnosed in children. It consists of glial cells, vascular tissue, and layers of pigment epithelial cells. The retinal pigmented epithelial hypertrophy and hyperplasia, as described earlier, are usually flat and jet-black color. tThe former have rounded or scalloped margins, while the latter have irregular borders[17]


A certain number of tumors can involve the optic nerve, including metastases, melanocytomas, hamartomas, uveal melanomas, retinoblastomas, hemangiomas, hemangioblastomas, medulloepitheliomas, juvenile xanthogranulomas, and intraocular extension of either optic nerve sheath meningiomas or optic nerve gliomas[4]
Melanocytomas of the optic nerve head were probably first observed shortly after the introduction of the ophthalmoscope in the mid-19th century. Many of the early reported cases of optic nerve melanocytomas were erroneously thought to be malignant, although some authors in the late nineteenth and early twentieth centuries believed these tumors might be benign. The definitive articles establishing the benign nature of optic nerve melanocytomas were published in 1959 and 1962. Zimmerman and Garron used the term melanocytoma to describe these magnocellular nevi of the optic nerve head and studied 20 enucleated specimens along with 14 clinical cases[4,12].
Melanocytomas are most common in patients with dark skin pigmentation; they occur slightly more often in females, and are usually detected in middle-aged patients. Melanocytomas are usually unilateral, although bilateral cases have been reported. They are generally asymptomatic, although in the case of extensive necrosis, a decrease in vision can occur. Retinal vascular alterations have been observed in 30%, subretinal fluid in 10%, and optic disc edema in 28% of cases. On long-term follow up, approximately 5% showed some deterioration of vision, 75% had an enlarged blind spot, 20% had arcuate scotomas, and 30% had an afferent pupil defect. The tumor borders may be sharp, but more commonly they are fibrillar due to infiltration of the nerve fiber layer. The average age at diagnosis was 50 years. Malignant transformation is extremely rare. Virtually all optic nerve melanocytomas can be observed without intervention. I have seen one case of malignant degeneration. In that case, the tumor was much larger than the typical melanocytoma, and a significant area of peripapillary choroid was also involved[4,12]. (Figure 16)
Juxtapapillary melanomas can simulate an optic nerve inflammation or a primary optic nerve tumor. Although there is a slight statistical increase in tumor-related mortality associated with melanomas around the optic nerve, this increase is observed only in tumors that actually compress the nerve, leading to a significant vision loss[4]
Occasional metastases initially involve only the optic nerve head[20, 39]. These are much less common than metastatic deposits in the uveal tract and occur with the same frequency as metastases involving the vitreous. Optic nerve infiltration may be a result of acute lymphocytic disorder. As previously discussed, both optic nerve gliomas and optic nerves heath meningiomas can invade the eye, causing intraocular involvement. Juvenile xanthogranuloma and malignant medulloepitheliomas have also rarely affected the optic disc; the latter tumor can result in mortality from contiguous spread to the central nervous system. Numerous other non-oncologic processes can produce enlargement of the optic nerve head. More common lesions that could be confused for a neoplastic process include acute anterior optic neuropathy (AION), buried optic nerve drusen, and tuberous sclerosis involving the disc[20]
Lymphoid lesions can involve all layers of the eye. Although these lesions are rare, leukemias, intraocular lymphoma, systemic lymphoma with secondary intraocular deposits, and benign lymphoid proliferations can all simulate solid intraocular tumors or inflammations of the optic nerve, retina, uvea, or vitreous[40]
Leukemic ophthalmopathy was first clinically described in 1861; before the advent of new tests and treatments, ocular findings were often an early diagnostic sign of leukemia. Most retinal findings in leukemia are not caused by neoplastic cells but by the associated hematologic abnormalities such as severe anemia, hypoxia, hyperviscosity, ischemia, and vascular stasis. Common retinal findings include hard exudates, cotton wool spots, tortuous veins, and intraretinal hemorrhages. Less commonly, in chronic leukemias, retinal changes can occur due to infectious processes or peripheral retinal neovascularization . Vascular sheathing is probably due to perivascular infiltrates. Numerous studies have shown no correlation between retinal involvement, prognosis, and the count of red cells, white cells, or platelets[4, 41]
Approximately 80% of leukemic patients show ocular involvement. In acute leukemia, this incidence has not changed despite treatment modifications over the years. Choroidal involvement is found in over 85% of eyes of patients with leukemia, but it is usually not clinically apparent. Occasionally, an exudative retinal detachment associated with choroidal infiltration is the first sign of leukemia. In adults, choroidal detachments due to diffuse leukemic infiltration can occur, and occasionally a mass can be present.
Optic nerve involvement in leukemia can result from direct extension from the CNS, passive swelling by a retrobulbar leukemic infiltration, or increased intracranial pressure. Optic nerve involvement usually occurs either in a relapse of CNS or in a patient with acute lymphocytic leukemia who did not receive prophylactic CNS treatment. Rarely, optic disc neovascularization occurs. Intrathecal chemotherapy is usually ineffective for acute leukemia of the optic nerve. However, local irradiation with only 8 Gy produces results in over 90 % of cases. Steroids can also be effective.
Long-term ophthalmic effects of treatment in children with acute lymphoblastic leukemia include cataracts and ocular abnormalities; however, all had normal vision and radiation retinopathy was not observed[4,41].
Intraocular lymphomas can be divided into broad categories: patients previously described as having intraocular lymphoma; patients who present with chorioretinal lymphoma and who often have both CNS and systemic involvement; and patients with systemic lymphoma who develop ocular involvement at an advanced stage of the disease[40,42,43].
Intraocular lymphoma is a rare intraocular neoplasm, often misdiagnosed as chronic diffuse uveitis. It usually develops in older patients, although there are patients in their twenties with this malignancy. Patients usually are reported with diffuse uveitis, for which they have been treated with steroids without any response or with exacerbation of their ocular signs and symptoms. In one-third of cases, CNS involvement occurs before the discovery of ocular disease. Initially, it was believed that intraocular lymphoma originated from the reticulum cells, but it is actually composed of malignant lymphocytes or precursors in various stages of differentiation[40,42,43]
Approximately 70 patients with primary intraocular lymphoma have been reported. As a general rule, any patient over the age 50 with new onset bilateral diffuse uveitis should be suspected of having intraocular lymphoma, although the disease is more common in older patients. Approximately 85% of patients with intraocular lymphoma eventually develop CNS lymphoma involvement, but CNS disease can occur before, during, or after the development of ocular disease. Bilateral ocular involvement is present in over 85 % of cases, although about one-third of patients may initially present with involvement of only one eye. Vitreous cells are usually present, with relatively mild or minimal anterior chamber reaction. (Figure 17) The anterior chamber reaction can be granulomatous or non-granulomatous. The pathognomonic lesions are white-yellow chorioretinal infiltrates. (Figure 18)
Rarely, hemorrhagic retinitis can simulate a cytomegalovirus (CMV) retinitis; however, lymphoma deposits are not usually perivascular, and unlike CMV retinitis, the hemorrhage is isolated.


Exudative detachment is present in 5% of cases. Patients with mainly vitreous involvement are more likely to develop CNS lymphoma compared to those with predominantly choroidal lymphoma; patients with non-vitreous choroidal lesions are more likely to develop systemic lymphoma[40,42,43]
Approximately 10% of these patients with intraocular lymphoma have a history of mild neurological deficit, usually manifesting as memory loss or a recent series of atypical minor cerebrovascular accidents. 30% of patients have neither a neurologic history, physical findings, nor laboratory results suggestive of underlying CNS or systemic lymphoma. In 60% of cases, simultaneous lymphoma of the eye and CNS is documented at the time of presentation. In this group, there are often no obvious neurological findings, and the diagnosis is made only through cerebrospinal fluid cytology or CNS imaging studies (MRI or CT with contrast) [40,42,43]
The diagnosis of intraocular lymphoma is established based on a fine needle aspiration biopsy (FNAB) of the vitreous; occasionally, a chorioretinal biopsy is required. There are three important caveats regarding the cytopathologic diagnosis of intraocular lymphoma. First, despite adequate cytologic material, the diagnosis could not be established based on a single vitreous biopsy. If the clinical suspicion is high, multiple or bilateral vitreous biopsies may be required. Second, the cytopathologic diagnosis is highly dependent on the quality of the cytopathologic preparation. Third, although some investigators have demonstrated that intraocular lymphomas can be monoclonal, in a small study conducted by our team, cytopathology proved to be more sensitive than immunologic techniques for establishing a diagnosis. The cytological features of intraocular lymphoma include cells with irregular nuclear contours and chromatin, lobation of nuclei, coarse, irregular chromatin, and the presence of nucleoli. Benign inflammatory cells are usually sparse[40,42,43].
A vitreous biopsy is diagnostic in all patients. If visual acuity is below 20/100 due to vitreous cell opacification, a vitrectomy may be performed at the time of biopsy. In all cases, bilateral bone marrow biopsies are performed, along with a lumbar puncture for cerebrospinal fluid cytology. As previously mentioned, approximately 80% of patients eventually develop CNS disease, which leads to death[40,42,43].
All patients with suspected intraocular lymphoma have complete CNS imaging studies. A thin-section magnetic resonance (MR) imaging scan is more sensitive than a contrast-enhanced computed tomography (CT) brain scan. However, thin-section CT is preferable to poor-quality MRI scan. If CT is used, intravenous contrast is mandatory to optimally visualize the lesion.
Treatment is controversial. It can be targeted as local therapy, which can be ocular radiotherapy or intracameral / intravitreal agents like methotrexate and rituximab, or as systemic therapy, which can be external beam radiotherapy or systemic chemotherapy[40,42,43]
Treatment guidelines are more difficult to establish for patients with isolated intraocular lymphoma. For lymphoma localized to the eye, the two options are to irradiate only the eye and serially monitor the CNS with brain MR scans and CSF cytology, or to irradiate both the eye and brain, with or without adjunctive chemotherapy. In 25% of patients with ocular lymphoma (primarily those with choroidal disease rather than vitreous involvement) systemic lymphoma not involving the CNS develops. These patients are treated with ocular irradiation and systemic chemotherapy[40,42,43]
After treatment of the eye with radiation, chemotherapy, or both, a consistent breakdown of the blood-aqueous barrier occurs; all these patients have persistent anterior chamber cells and flare. Similarly, if a central vitrectomy has been performed, peripheral vitreous opacifi-
cation remains stationary despite effective treatment. All patients are followed by an oncologist[40,42,43]
Benign and malignant lymphoid tumors involving the uveal tract have been reported since 1920. These tumors may be localized choroidal lymphomas, consisting of a benign uveal infiltrate, or can contiguously involve the uveal tract, sclera, optic nerve, and orbit. Cookes and Mullaney first reported a case of lymphoid hyperplasia of the uveal tract in 1967. Ryan and colleagues retrospectively analyzed histological data on 19 cases showing massive uveal lymphoid involvement without scleral inflammation. Seventeen of the 19 patients had unilateral disease that simulated a melanoma. The average age of onset was 55 years, with a range of 30 to 94 years. Most patients presented due to vision loss; however, retinal detachment with glaucoma and/or iridocyclitis occurred, and some patients initially sought care due to inflammation or pain. Histologically, mature lymphocytes were observed in the uveal tract of all patients, and most also had plasma cells. Only one patient showed an abnormality in serum protein electrophoresis.
Very few clinical reports have been published on these intraocular lymphoid tumors. They are usually associated with localized extraocular lymphocytic infiltration[40,42,43]
Many cases of benign uveal lymphoid lesions respond to steroids. In a single reported case, irradiation also appeared to be effective, and good results were achieved with three patients treated with 20 Gy of photon radiation.
Benign uveal lymphoid lesions may also occur as part of the spectrum of conditions associated with idiopathic posterior scleritis. Most of these patients have an exudative detachment of the choroidal and/or retina without an obvious mass. Many patients with posterior scleritis exhibit mild anterior segment inflammation; a number of them have been reported with false positive radioactive phosphorus uptake tests[40,42,43]
The management of either posterior scleritis or benign uveal lymphoid lesions is unclear. Some patients respond to oral steroids (10 days of 80 mg of daily oral prednisone). Finally, it is important to emphasize that intraocular inflammation does not exclude the diagnosis of a uveal melanoma. A small percentage of patients, typically those with large, necrotic uveal melanomas, can present with intraocular inflammation as a sign[40,42,43]
References
1. Singh, A.D., M.E. Turell, and A.K. Topham, Uveal melanoma: trends in incidence, treatment, and survival. Ophthalmology, 2011. 118(9): p. 1881-5.
2. Abdolrahimzadeh, S., et al., An update on ophthalmological perspectives in oculodermal melanocytosis (Nevus of Ota). Graefes Arch Clin Exp Ophthalmol, 2023. 261(2): p. 291-301.
3. Jager, M.J., et al., Uveal melanoma. Nat Rev Dis Primers, 2020. 6(1): p. 24.
4. Carol L. Shields, J.A.S., Intraocular Tumors: An Atlas and Textbook, ed. L.W.a. Wilkins. 2015.
5. Chattopadhyay, C., et al., Uveal melanoma: From diagnosis to treatment and the science in between. Cancer, 2016. 122(15): p. 2299-312.
6. Kaliki, S. and C.L. Shields, Uveal melanoma: relatively rare but deadly cancer. Eye (Lond), 2017. 31(2): p. 241-257.
7. Almeida, A., S. Kaliki, and C.L. Shields, Autofluorescence of intraocular tumours. Curr Opin Ophthalmol, 2013. 24(3): p. 222-32.
8. Gunduz, K., et al., Review of fundus autofluorescence in choroidal melanocytic lesions. Eye (Lond), 2009. 23(3): p. 497-503.
9. Kivela, T., Diagnosis of uveal melanoma. Dev Ophthalmol, 2012. 49: p. 1-15.
10. Solnik, M., et al., Imaging of Uveal Melanoma-Current Standard and Methods in Development. Cancers (Basel), 2022. 14(13).
11. Chien, J.L., et al., Choroidal nevus: a review of prevalence, features, genetics, risks, and outcomes. Curr Opin Ophthalmol, 2017. 28(3): p. 228-237.
12. Khadem, J.J. and J.J. Weiter, Melanocytomas of the optic nerve and uvea. Int Ophthalmol Clin, 1997. 37(4): p. 149-58.
13. Shields, C.L., et al., Small choroidal melanoma: detection with multimodal imaging and management with plaque radiotherapy or AU-011 nanoparticle therapy. Curr Opin Ophthalmol, 2019. 30(3): p. 206-214.
14. Sobottka, B. and I. Kreissig, Ultrasonography of metastases and melanomas of the choroid. Curr Opin Ophthalmol, 1999. 10(3): p. 164-7.
15. Callaway, N.F. and P. Mruthyunjaya, Widefield imaging of retinal and choroidal tumors. Int J Retina Vitreous, 2019. 5(Suppl 1): p. 49.
16. Verbeek, S. and L.A. Dalvin, Advances in multimodal imaging for diagnosis of pigmented ocular fundus lesions. Can J Ophthalmol, 2024. 59(4): p. 218-233.
17. Shields, J.A. and C.L. Shields, Tumors and Related Lesions of the Pigmented Epithelium. Asia Pac J Ophthalmol (Phila), 2017. 6(2): p. 215-223.
18. Branisteanu, D.C., et al., Uveal melanoma diagnosis and current treatment options (Review). Exp Ther Med, 2021. 22(6): p. 1428.
19. Jouhi, S., et al., The Small Fatal Choroidal Melanoma Study. A Survey by the European Ophthalmic Oncology Group. Am J Ophthalmol, 2019. 202: p. 100-108.
20. Mathis, T., et al., New concepts in the diagnosis and management of choroidal metastases. Prog Retin Eye Res, 2019. 68: p. 144-176.
21. Singh, A.D., P.K. Kaiser, and J.E. Sears, Choroidal hemangioma. Ophthalmol Clin North Am, 2005. 18(1): p. 151-61, ix.
22. Shields, C.L., et al., Circumscribed Choroidal Hemangioma: Visual Outcome in the Pre-Photodynamic Therapy Era versus Photodynamic Therapy Era in 458 Cases. Ophthalmol Retina, 2020. 4(1): p. 100-110.
23. Shields, C.L., J.A. Shields, and J.J. Augsburger, Choroidal osteoma. Surv Ophthalmol, 1988. 33(1): p. 17-27.
24. Shields, C.L., et al., Choroidal melanoma: clinical features, classification, and top 10 pseudomelanomas. Curr Opin Ophthalmol, 2014. 25(3): p. 177-85.
25. Carvajal, R.D., et al., Metastatic disease from uveal melanoma: treatment options and future prospects. Br J Ophthalmol, 2017. 101(1): p. 38-44.
26. Salowe, R. and J.M. O’Brien, The Collaborative Ocular Melanoma Study Randomized Trial of Iodine 125 Brachytherapy for Choroidal Melanoma. Ophthalmology, 2020. 127(4S): p. S146-S147.
27. Singh, A.D. and T. Kivela, The collaborative ocular melanoma study. Ophthalmol Clin North Am, 2005. 18(1): p. 129-42, ix.
28. Finger, P.T., Radiation therapy for choroidal melanoma. Surv Ophthalmol, 1997. 42(3): p. 215-32.
29. Wen, J.C., S.C. Oliver, and T.A. McCannel, Ocular complications following I-125 brachytherapy for choroidal melanoma. Eye (Lond), 2009. 23(6): p. 1254-68.
30. Midena, E., et al., The effect of external eye irradiation on choroidal circulation. Ophthalmology, 1996. 103(10): p. 1651-60.
31. Midena, G., et al., Chorioretinal Side Effects of Therapeutic Ocular Irradiation: A Multimodal Imaging Approach. J Clin Med, 2020. 9(11).
32. Nathan, P., et al., Overall Survival Benefit with Tebentafusp in Metastatic Uveal Melanoma. N Engl J Med, 2021. 385(13): p. 1196-1206.
33. Shields, J.A., Photodynamic therapy for choroidal hemangioma. Graefes Arch Clin Exp Ophthalmol, 2006. 244(9): p. 1071-2.
34. Finger, P.T., Radiation therapy for exudative choroidal hemangioma. Indian J Ophthalmol, 2019. 67(5): p. 579-581.
35. Karimi, S., et al., Von Hippel-Lindau Disease and the Eye. J Ophthalmic Vis Res, 2020. 15(1): p. 78-94.
36. Wiley, H.E., et al., Management of Retinal Hemangioblastoma in Von Hippel-Lindau Disease. Retina, 2019. 39(12): p. 22542263.
37. Peng, M.Y., A. Agarwal, and H.R. McDonald, Multimodal Imaging Findings in a Retinal Astrocytic Hamartoma. Ophthalmology, 2021. 128(1): p. 99.
38. Sen, M., et al., Coats disease: An overview of classification, management and outcomes. Indian J Ophthalmol, 2019. 67(6): p. 763-771.
39. Kongwattananon, W., T. Pothikamjorn, and T. Somkijrungroj, Posterior segment manifestations of ocular metastasis. Curr Opin Ophthalmol, 2023. 34(6): p. 522-528.
40. Tang, L.J., C.L. Gu, and P. Zhang, Intraocular lymphoma. Int J Ophthalmol, 2017. 10(8): p. 1301-1307.
41. Coupland, S.E. and B. Damato, Understanding intraocular lymphomas. Clin Exp Ophthalmol, 2008. 36(6): p. 564-78.
42. Chan, C.C. and D.J. Wallace, Intraocular lymphoma: update on diagnosis and management. Cancer Control, 2004. 11(5): p. 285-95.
43. Goldberg, S., et al., Intraocular lymphoma. Ophthalmology, 2007. 114(6): p. 1236-7.

